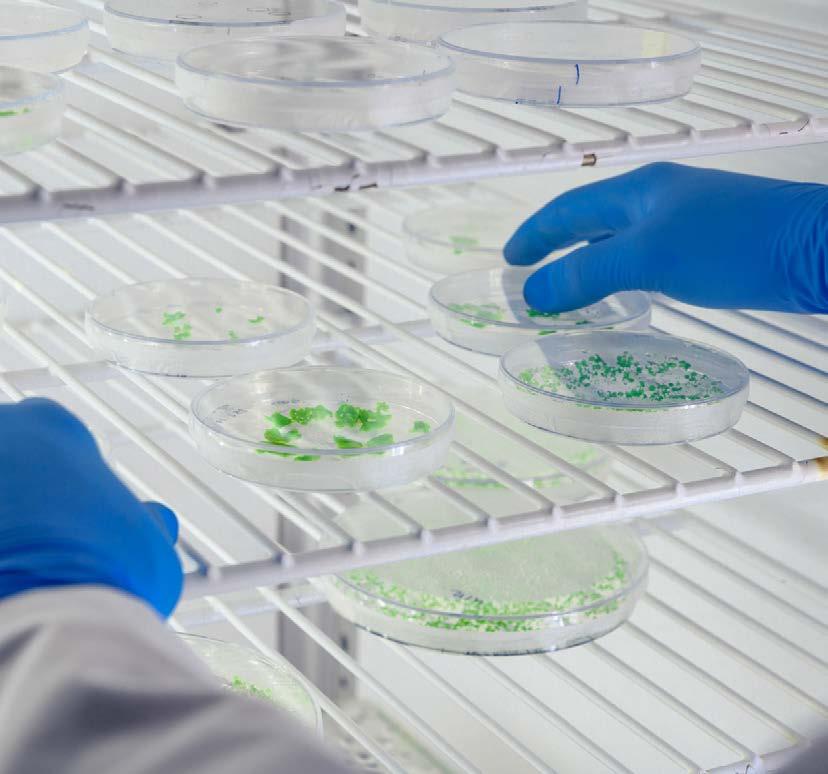

KVANT UM TIM
Put u zdravu budućnost

![]()
KVANT UM TIM
Put u zdravu budućnost



KVANT UM TIM Put u zdravu budućnost
Vaš partner za digitalna medicinska rješenja
EKG uređaji 8-13
Papiri za EKG uređaje 13-14
Dodaci za EKG uređaje 15
Telemedicina 16
Holteri tlaka 17
Test trake i bicikli 18
Ergometri i traka za trčanje 19
Monitori vitalnih funkcija 20-21

Dijagnostički UZV 22-24
Dodaci za dijagnostički UZV 25
CTG dopleri i monitori 26-28
Littmann stetoskopi 29-32
Littmann potrošni materijal za stetoskope 32
Stetoskopi 33-35
Dodaci za stetoskope 35
Otoskopi 36-37
Video otoskop 38
Ušni lijevci za otoskope 38
Dodaci za otoskope 39
Oftalmoskopi 39-40
Dodaci za oftalmoskope 40
Dijagnostički kompleti otoskop /oftalmoskop 41-42
Dermatoskopi 43
Kolposkopi 44-45
Stalci za kolposkope 45
Mikroskopi 46
Skeneri vena 47
Dijagnostičke svjetiljke 47 Čeona svjetla i ogledala 48-49
Binokularne lupe 49
Refleksni čekići 50
Anoskopi i proktoskopi 50
ROSSMAX | Zdravstvena stanica 52
Profesionalni tlakomjeri 53-56
Digitalni tlakomjeri 58-60
Manžete i rezervni dijelovi za tlakomjere 60
Beskontaktni toplomjeri 61
Digitalni toplomjeri 62

Audiometri 63-64
Zvučne vilice 64
Spirometri 65-67
Dodaci za spirometre 68
Respiratorni program 68-69
Uređaji za analizu tjelesne mase 70-71
Profesionalne vage i visinomjeri 72-75
Vage za bebe i djecu 76-78
Uređaji za mjerenje opsega 78
Dužinomjeri za dječje vage 79
Torbe za SECA vage 80
Osobne digitaln vage 81-82
Osobne mehaničke vage 82
Medicinski mjerni uređaji 83
Ispitivanje vida 84
INSTRUMENTI I POSUĐE
Medicinske pincete 87-88


Medicinske škare 89-91
Instrumenti s pozlaćenom drškom 91
Medicinske hvatalice i iglodržači 92-93
Medicinska kliješta 94-95
Medicinski spekulumi 96
Ostali medicinski instrumenti 97-100
Medicinsko posuđe 101-102
Sterilizatori 104
Potrošni materijal za sterilizatore 104 Autoklavi 105-106

Uređaji za zavarivanje vrećica za autoklave 107
Potrošni materijal za autoklave 107
Germicidne lampe 108-109
Dispenzeri za papirnate ručnike 110
Celulozna vata i papirnati ručnici 110
Dispenzeri za dezinfekcijska sredstva i sapune
Plastični spremnici za odlaganje igala i infektivnog otpada 112 Kolica za čišćenje i kante za otpad 112 05


Defibrilatori Saver One 132-133

Pribor za Saver One defibrilatore 133
Defibrilatori 134
Ormarići za defibrilatore 135
Defibrilatori PRIMEDIC 136-137
Električni kompresor za prsa 138
Laringoskopi 139-140
Proizvodi za reanimaciju 141-143
Ormarići za prvu pomoć 144
Kompleti za prvu pomoć 144
Torbe i ruksaci za hitnu pomoć | PraznI 144-145
Nosila i oprema za imobilizaciju 146-148
Respiratorni program | Terapija kisikom 149
Respiratorni program | Koncentratori kisika 150
Respiratorni program | Apneja 151
Respiratorni program | Aspiratori 152-155
Pulsni oksimetri 156-157
PROIZVODI I UREĐAJI
Dijagnostički uređaji 160-162

Laboratorijski uređaji 163
Terapijski uređaji 163
Terapija kisikom | Boce za kisik 164
FLAEM | Aspiratori i potrošni materijal 164
ROSSMAX | Aspiratori i potrošni materijal 165
Proizvodi za reanimaciju 165
Medicinske škare 166-167
Medicinske hvatalice i iglodržači 168
Medicinske pincete 169
Medicinski skalpel nožići 169
Medicinsko posuđe 170
Igle za biopsiju 170
Jednokratna sterilna klamerica 170
Veterinarske trakice za urin - 11 parametara 170
Veterinarski operacijski stolovi 171
Vage 171
Jednokratne zaštitne rukavice 172-173
Zaštitne maske za lice 173
Zaštitne naočale 173
Poveska za uzimanje krvi s brzom kopčom 173
Jednokratne škare za uklanjanje kopči 173
Potrošni materijal 174
Plastični spremnici za odlaganje igala i infektivnog otpada 174
Pregledni ležajevi 176-179

Potrošni materijal za pregledne ležajeve 179
Kolica za prijevoz pacijenta | strecheri 180-181
Operacijski stolovi 182-184

Bolnički kreveti 185-188
Madraci za bolničke krevete 188
Noćni ormarići 189
Rješenja i sustavi poziva medicinskih sestara 190-191
Dodaci za bolničkie krevete 192
Stalci za infuziju 193
Paravani 194
Stepenice 194
Medicinska kolica za instrumente
Medicinski stolići za instrumente
Kolica za lijekove
Kolica za reanimaciju
Kolica i stolići za previjanje
Kolica za čisto i nečisto
09

10








Igle 228
Kanile 229
Hijaluronski fileri 229
Pribor za uzimanje uzoraka 230-231
Flasteri, zavoji i komprese 232-233
Specijalistički potrošni materijal 234
Razni potrošni materijal 235
Jednokratne zaštitne rukavice 236-237
Zaštitne maske za lice 237
Zaštitne naočale 237
Zaštitna jednokratna odjeća 238
Invalidska kolica 240-242

Rolatori 242-243
Hodalice 244
Štapovi za hodanje 244-245
Toaletna kolica

246
Toaletni stolci 247
Stolci za tuširanje 247-248
Pomagala za tuširanje 248-249
Toaletna povišenja 250
Noćne i urološke posude 251
Stolići za hranjenje 252
Kreveti za njegu bolesnika 254
Antidekubitalni madraci 255
Jastuci protiv dekubitusa i hemeroida 256-257
Električne grijaće deke i jastuci 258
Zdravstvene lift fotelje 259
Termofori 260
Topli pojas za struk 260
Inhalatori | FLAEM 261-262
Potrošni materijal za inhalatore | FLAEM 262-263
Inhalatori | ROSSMAX 264-266
Potrošni materijal za inhalatore | ROSSMAX 266
Sustav za poziv njegovatelju
13
LIJEČNIČKE TORBE I MEDICINSKA OBUĆA

14
Modeli lutaka za edukaciju reanimacije 278-279 Uređaji za edukaciju defibrilacije 280 Anatomski posteri i modeli 280-281


iMAC120pro EKG uređaj
12-kanalni profesionalni EKG.
Zahvaljujući jedinstvenoj tehnologiji filtera i pisaču, omogućuje najsofisticiraniji i najdetaljniji prikaz valova.
Šifra
01.1.5796.00
Simultano snimanje svih 12 kanala, 4 bita A/D konverzija, uzorkovanje 32.000 uzoraka/sekundi, FT LCD zaslon u boji, dijagonale 20 cm prikazuje svih 12 valnih oblika/odvoda, frekvenciju srca, spoja odvoda i pacijentom, mod rada, filtere, osjetljivost, brzinu papira, ID pacijenta, ime, spol, dob, alarmne poruke, stanje baterije, indikacija napajanja (AC/bat.), oznaku SD kartice, zbornik, poruke i ispis na hrvatskom jeziku. Izbor prikaza odvoda na cjelom zaslonu: 3×4, 3×4+1R, 6×2, 6×2+1R, 12×1; prikaz na podjeljenom zaslonu: 3×4, 6×2. Funkcijske tipke za brzi pristup, MG filter 25/ 35/ 45/ 75/ 100/ 150 / 350Hz, filter osnovne linije 0.05/ 0.3/ 0.6Hz, C filter 50/60 Hz. Specijalne akvizicijske funkcije / prikazi: detekcija odspojenog odvoda, zasičenje signala odvoda, AC, EMG interferencija i interferencija osnovne linije, defibrilatorska zaštita.

6-kanalni profesionalni EKG.
Zahvaljujući jedinstvenoj tehnologiji filtera i pisaču, omogućuje najsofisticiraniji i najdetaljniji prikaz valova.
Šifra
01.1.5795.00
10,4-inčni HD LED zaslon osjetljiv na dodir sa standardnom pozadinom koji omogućuje ispis papira bez mreže. Vanjski laserski pisač za ispis A4 izvješća, skener, čitači kartica i drugi uređaji za unos podataka o pacijentu. EKG izvješće poslano e -poštom s uređaja na računalo ili pametni telefon putem WiFi -a ili WLAN -a izravno. Prijenos podataka EKG -a u XML, PDF i PNG formatu na PC, PaCS ili informacijski sustav putem Etherneta. Ugrađena litij-ionska baterija podržava rad najmanje 2 sata, memorija do 1000 EKG -ova u mirovanju, proširena SD karticom, USB flash diskom ili mrežnom memorijom. Podržava Wifi i povezivanje putem kabla koji se povezuje na EKG mrežni sustav treće strane, HIS i EMR sustav bez EKG radne stanice.

Tehničke karakteristike:
• ispis na grafički pisač sa termičkom glavom
• ispis svih 12 kanala i svih relevantnih parametra i podataka na termo papir formata A4
• brzina ispisa na papir: 5, 6.25, 10, 12.5, 25, 50 mm/s
• podržan ispis na vanjski laserski A4 standardni pisač
• mjerenjem, analiza i interpretacija za odrasle i djecu
• radni modovi: automatski, manualni, ritam mod, triger mod
• DEMO mod rada uređaja: normalni EKG ili EKG sa aritmijom
• analiza ritma na jednom odvodu traje 30 – 300 sek., analiza na 3 odvoda traje 30 -100 sek. po odvodu
• podržan produženi ispis valnog oblika aritmije u automatskom modu
• podržano zamrzavanje valnog oblika
• detekcija pacemaker-a slabog, normalnog i povećanog signala
• izbor autoomatskog pohranjivanja izvještaja u datoteku
• izbor ispisa interpretacije
• formati zapisa u datoteku: PNG / DICOM / XML / ZQECG / HL7 / PDF
• direktno slanje izvještaja na e-mail
• podržano spajanje na HIS i EMR sustav bez EKG radne stanice
• vizualni alarm za: odspojeni odvod, nema papira, prazna baterija
• kapacitet lokalne memorije 1000 zapisa / datoteka
• vrste ispisa: manualni ispis, jednostavan ispis, detaljan ispis
• formati ispisa: 3*4, 3*4+1R, 3*4+3R
• USB sučelje
• LAN RJ-45 za povezivanje
• napajanje AC/DC, 220V/50Hz / punjiva Litium baterija
• kapacitet baterije 3 sata kontinuiranog rada
• punjenje baterije do 4 sata skroz prazne baterije
• dimenzije : 285x360x94 mm / težina 3,6 kg
Šifra papira: 01.4.5807.00

Tehničke karakteristike:
• brzina uzorkovanja: 32000Hz (1ms)
• način unosa: plutajući ulaz
• razina buke: ≤ 10μVp p
• CMRR: ≥ 130 dB
• struja propuštanja pacijenta: <10µA
• ulazni krug: <50μA
• frekvencijski odziv: 0,01 ~ 350Hz
• vremenska konstanta: ≥ 3,2 s
• napon polarizacije: ± 610mV ± 1%
• kalibracijski napon: 1mV ± 2%
• brzina papira: 5, 6.25,12.5, 25, 50 mm/s
• veličina papira: termalni preklopni papir 112 mm × 20 m
• ulazna impedancija: ≥ 50MΩ (10 Hz)
• osjetljivost: 2,5, 5, 10, 20, 40, 10/5, auto mm/mV
• način snimanja: Pisač s termalnim nizom 8 točaka/ mm (okomito) i 40 točaka/ mm (vodoravno, 25 mm/ s
• kontinuirani rad: AC ≥ 8h; DC ≥ 5h
• A/D pomak: 24 bita
• pohrana podataka: maks. 1000 kompleta; podrška za SD karticu, USB
Standardna isporuka:
• iMAC 12 EKG uređaj (s baterijom)
• papir za ispis
• kabel za napajanje
• žica za uzemljenje
• kabel za pacijenta
• korisnički priručnik
• elektrode za prsa
• elektrode udova
Šifra papira: 01.4.5806.00


3-kanalni profesionalni EKG.
Zahvaljujući jedinstvenoj tehnologiji filtera i pisaču, omogućuje najsofisticiraniji i najdetaljniji prikaz valova.
Šifra
01.1.5794.00
Simultano snimanje svih 12 kanala. 24 bita A/D konverzija, uzorkovanje 32.000 uzoraka/sekundi.
TFT LCD zaslon u boji, dijagonale 14,2 cm prikazuje svih 12 valnih oblika/odvoda, frekvenciju srca, spoja odvoda i pacijentom, mod rada, filtere, osjetljivost, brzinu papira, ID pacijenta, ime, spol, dob, alarmne poruke, stanje baterije, indikacija napajanja (AC/bat.), oznaku SD kartice. Izbornik, poruke i ispis na hrvatskom jeziku, izbor prikaza odvoda na cjelom zaslonu: 3×4, 3×4+1R, 6×2, 6×2+1R, 12×1; prikaz na podjeljenom zaslonu: 3×4, 6×2. Funkcijske tipke za brzi pristup. EMG filter 25/ 35/ 45/ 75/ 100/ 150Hz, filter osnovne linije 0.05/ 0.3/ 0.6Hz, AC filter 50/60 Hz. Specijalne akvizicijske funkcije / prikazi: detekcija odspojenog odvoda, zasičenje signala odvoda, AC, EMG interferencija i interferencija osnovne linije. Defibrilatorska zaštita.
Tehničke karakteristike:

12-kanalni profesionalni EKG.
01.1.3324.00

• ispis na grafički pisač sa termičkom glavom
• ispis svih 12 kanala na roli papira širine 80 mm i svih relevantnih parametra i podataka
• brzina ispisa na papir: 5, 6.25, 10, 12.5, 25, 50 mm/s
• podržan ispis na vanjski laserski A4 standardni pisač
• mjerenjem, analiza i interpretacija za odrasle i djecu
• radni modovi: automatski, manualni, ritam mod, triger mod
• DEMO mod rada uređaja: normalni EKG ili EKG sa aritmijom
• analiza ritma na jednom odvodu traje 30 – 300 sek., analiza na 3 odvoda traje 30 -100 sek. po odvodu
• podržan produženi ispis valnog oblika aritmije u automatskom modu
• podržano zamrzavanje valnog oblika
• detekcija pacemaker-a slabog, normalnog i povećanog signala
• izbor autoomatskog pohranjivanja izvještaja u datoteku
• izbor ispisa interpretacije
• formati zapisa u datoteku: PNG / DICOM / XML / ZQECG / HL7 / PDF
• direktno slanje izvještaja na e-mail
• podržano spajanje na HIS i EMR sustav bez EKG radne stanice
• vizualni alarm za: odspojeni odvod, nema papira, prazna baterija
• kapacitet lokalne memorije 1000 zapisa / datoteka
• vrste ispisa: manualni ispis, jednostavan ispis, detaljan ispis
• formati ispisa: 3*4, 3*4+1R, 3*4+3R
• USB sučelje
• LAN RJ-45 za povezivanje
• napajanje AC/DC, 220V/50Hz / punjiva Litium baterija
• punjenje baterije do 4 sata skroz prazne baterije
• dimenzije : 260x180x55 mm / težina 1,2 kg
Šifra papira: 01.4.5805.00

Contec EKG 1200G je elektrokardiogram koji može istodobno prikazati dvanaesterostruki EKG signal i ispisati EKG valni oblik putem ugrađenog pisača na principu toplinskog ispisa (ispis na papiru 210 mm širine. Sadrži, snima i prikazuje EKG valni oblik u AUTO / ručnom načinu rada, automatski mjeri i dijagnosticira parametre EKG valnog oblika. Contec EKG 1200G upozorava na nedostatak papira, nepostojanje kontakta s elektrodama. Prikaz 3/6/12 kanalnog EKG-a, moda ispisa, osjetljivosti, brzine papira i stanja filtra itd. Brzina papira: 5mm / s, 6,25mm / s, 10mm / s, 12,5mm / s, 25mm / s, 50mm / s. Uz funkcije automatske analize i automatske dijagnoze za rutinske EKG parametre, Contec EKG 1200G daje rezultate mjerenja i zaključke auto-dijagnoze za HR, PR interval, P Trajanje, QRS Trajanje, T Trajanje, QT interval, Q-Tc, P Os , QRS-osi, T-osi, R (V5), S (V1), R (V5) + S (V1) itd., što rad liječnika čini lakšim i bržim. U ugrađenu memoriju moguće je pohraniti do 1000 slučajeva koje je moguće pregledavati i koristiti za potrebe statistike. Sučelje i izvješće moguće je postaviti na više jezika (turski, francuski, kineski, engleski, njemački, kazaški, poljski, portugalski, ruski, slovenski, španjolski i ukrajinski). U optimalnom stanju može raditi do 10 sati na standby modu, više od 3 sata pri kontinuiranom ispisu, snimiti do 300 EKG valnih oblika. Tehničke karakteristike:
• TFT LCD zaslon u boji od 8’’ prikazuje radni status i EKG-valove.
• Nudi mogućnost provjere vala prije ispisa radi uštede papira za ispis.
• Dobivanje EKG valova visoke kvalitete pomoću AC, DFT i EMG-filtera.
• Uređaj radi na principu digitalne signalne obrade.
• Istovremeni prikaz EKG vala s 3/6/12 izvoda te načina, osjetljivosti, brzine i filtera ispisa olakšava kontrastnu dijagnozu.
• Više različitih načina i formata ispisa, uključujući 12*1, *2+1 (izvod za ritam), 6*2, ritam 12, ritam 10, ritam 8, ritam 6, ručni i “freeze”, itd.
• Automatska analiza i dijagnostika.
• Napajanje: AC/DC, ugrađena punjiva baterija. AC - 100 V~240 V, 50/60 Hz; DC - 14,8 V, punjiva litijska baterija od 3700 mAh. Zaštita od dozemnog spoja i defibrilacije.
• Struja curenja kroz pacijenta: <10μA.
• Parametri mjerenja: HR, P-R interval, trajanje P intervala, trajanje QRS kompleksa, trajanje T intervala, Q-T interval, Q-Tc,S P Axis, QRS Axis, T Axis, R(V5), S(V1), R(V5)+S(V1). Razina šuma: ≤15 μVp-p.
Šifra papira: 01.4.5755.00

6-kanalni EKG uređaj koji istovremeno bilježi 12 izvoda i ispisuje EKG valove pomoću sustava za termalni ispis.
Šifra
01.1.5493.00
LCD zaslon: 800×480 TFT; prikazuje radni status i EKG valove. Dodirni zaslon i mekana tipkovnica olakšavaju rad. Dobivanje EKG valova visoke kvalitete pomoću AC filtera, filtera bazne linije i EMG filtera za EKG signal. Istovremeno prikazivanje 3/6/12 izvoda EKG valova te načina rada pisača, osjetljivosti ispisa, brzine i filtera olakšava intepretaciju. Istovremeno prikazivanje 12 izvoda, digitalni signalni procesor. Radni kapacitet uređaja pri potpunoj napunjenosti baterije: standby-način rada: 4 sata, kontinuirani ispis: 90 minuta, ispis 150 snimaka EKG valova. Ugrađen sustav za pohranu podataka velikog kapaciteta koji memorira više od 1000 pregleda, što liječniku omogućava uvid u statistiku rezultata.

Tehničke karakteristike:
• Ulaz: zaštita od dozemnog spoja i defibrilacije
• Odvodi: standardnih 12 odvoda
• Struja curenja kroz pacijenta: <10μA
• Ulazna impedancija: ≥50MΩ -3,0 dB
• Frekvencija odziva: 0,05Hz ~ 150 Hz +0,4dB
• Vremenska konstanta: >3,2 s




• Odabir osjetljivosti: 5/10/20 mm/mV, pogreška: ±5%. Standardna osjetljivost: 10 mm/mV ±0,2 mm/mV
• Automatski ispis: ispis prema namještenom formatu i automatskom načinu mjerenja, automatski prekidač za odvode, automatsko mjerenje i analiza.
Šifra papira:
01.4.5754.00

Trokanalni EKG-uređaj s TFT-zaslonom od 3,5’’.
Šifra
01.1.1007.00
• CMRR (omjer potiskivanja pogreške od napona zajedničkog potencijala): >60dB
• Filter EMG-interferencija: 25Hz/35Hz +0,4dB -3,0 dB
• Način snimanja: Sustav za termalni ispis
• Specifikacija papira za ispis: termalni papir koji se brzo ispisuje, 110 mm (š)×20 m (d)
• Brzina papira: Automatski ispis: 6,25 mm/s, 12,5 mm/s, 25 mm/s, 50 mm/s, pogreška: ±5%
• Ritmički ispis: 6,25 mm/s, 12,5 mm/s, 25 mm/s, 50 mm/s, pogreška: ±5%
• Ručni ispis: 6,25 mm/s, 12,5 mm/s, 25 mm/s, 50 mm/s, pogreška: ±5%

Istovremeni prikaz 12 izvoda. Sustav za termalni ispis. Ugrađena litijska punjiva baterija omogućava snimanje do 150 EKG snimaka. Ugrađena baza za pohranu više od 1000 podataka. Funkcija automatskog mjerenja, analize i interpretacije. Parametri mjerenja: HR, P-R interval, trajanje P intervala, trajanje QRS kompleksa, Q-T interval, Q-Tc,S P Axis, Axis, R(V5), S(V1), R(V5)+S(V1).
Tehničke karakteristike:
• Standardnih 12 izvoda.
• Struja curenja kroz pacijenta Ulazna impedancija ≥50 MΩ
• Frekvencija odziva: 0,05-150 Hz.
• Vremenska konstanta: >3,2s
• CMRR (omjer potiskivanja pogreške od napona zajedničkog potencijala): 10 kom
• Papir: 80 mm × 20 m
• Brzina ispisa: 25 i 50 mm/s
• Mogućnost odabira osjetljivosti ispisa: 5, 10, 20 mm/m
• Trajni polarizacijski napon: ±500 mV
• Razina šuma: ≤15 μVp-p
Šifra papira: 01.4.5321.00

• Ručni ispis: ispis prema namještenom formatu, ručni prekidač za odvode.
• Parametri mjerenja: HR, P-R interval, trajanje P-intervala, trajanje QRS-kompleksa, trajanje T-intervala, Q-T interval, Q-Tc, P Axis, QRS Axis, T Axis, R(V5), S(V1), R(V5)+S(V1).
• Sigurnosni razred proizvoda: Klasa I, tip CF, primijenjeni dio za zaštitu od defibrilacije
• Trajni polarizacijski napon: ±300 mV
• Razina buke: ≤15μVp-p
• Specifikacija osigurača: 2 kom 5×20 mm AC tromi osigurač: T1.6AL250V
• Dimenzije: 315 mm(d)×215 mm(š)×77 mm(v)
• Neto težina: 2,25 kg
CONTEC E3 Digitalni EKG Monitor
3-kanalni EKG s 12 odvoda, printerom i 4,3 inčnim zaslonom
• Dimenzije: 315 mm × 200 mm × 77 mm.
• Težina: 1,6 kg.

CONTEC E6 TOUCH Digitalni EKG uređaj
6-kanalni EKG s 12 odvoda i zaslonom osjetljivim na dodir
• Dimenzije: 315 mm × 200 mm × 92 mm.
• Težina: 1,7 kg.

12-kanalni EKG s 12 izvoda.

EKG nove generacije, pruža sveobuhvatan skup alata za kardiološku dijagnostiku.
Sveobuhvatna rješenja za kardiološku praksu:
• Standardni elektrokardiogram s 12 odvoda u mirovanju
• Elektrokardiogram s 9 odvoda u mirovanju prilagođen za novorođenčad
• Vektorski EKG i vremenski vektorski EKG (VCG i TVCG)
• Analiza uprosječenog EKG signala (SAECG)
• Varijabilnost optkucaja srca (HRV)
• Prikaz ST-segmenta (intuitivni prikaz ST-segmenta)
• Kalkulacija 18 odvoda s izvještajem

12-kanalni EKG s 12 izvoda.
Praktičan je EKG uređaj osmišljen kako bi pojednostavio tijek rada u zdravstvenoj skrbi. Uređaj automatski bilježi EKG čim se signali uzorkuju na zadovoljavajućoj razini, uz pravovremeno upozorenje u slučaju pogrešnog spajanja vodova ili detekcije elektrostimulatora srca.
Karakteristike uređaja:
• Inteligentno uzorkovanje
• Detekcija elektrostimulatora srca
• Samoprilagodljivi AC filter
• Ukazivanje na ozbiljne bolesti
• Upozorenje na pogrešno spojene elektrode
3-kanalni EKG.

Kombinacijom lagane konstrukcije i kompaktnog dizajna, SE-310 EKG predstavlja savršen alat za medicinske stručnjake u pokretu. Bez obzira radi li se o klinikama, ordinacijama opće prakse ili rehabilitacijskim ustanovama, ovaj prijenosni uređaj omogućuje trenutnu i preciznu dijagnostiku.
Tehničke karakteristike:
• CMRR (Common Mode Rejection Ratio)
• Širina frekvencijskog pojasa
• Brzina uzorkovanja
• Detekcija kvalitete signala
• Pouzdani EKG algoritam
• Dijagnostika na zaslonu
12-kanalni EKG s 12 izvoda.
01.1.5777.00
Tehničke karakteristike:
• Zaštita od defibrilacije.
• Napajanje kroz el. mrežu ili rad na bateriju.
• Radni kapacitet 400 snimaka ili 3,5 sata praćenja).

• Alfanumerička tipkovnica za unos podataka o pacijentu.
• Način rada: automatski, ručni, ritam, trend ritma (opcionalno).
• Istovremeni ispis 12 kanala na papirširine 210 mm.
• Brzina ispisa: 5-10-12,5-25-50 mm/s
• Memorija: 200 EKG snimaka.
• Ugrađeni filteri: AC, EMG, DFT
• Prepoznavanje pacemakera
• Priključci: LAN, serijski
• Dimenzije: 420x330x120 mm
• Težina: 5 kg
Šifra papira: 01.4.5793.00 EDAN SE-1200 Express

Šesterokanalni EKG s 12 izvoda. Kompaktan i lagan uređaj s velikim LCD 5.7’’ zaslonom.
Šifra
01.1.5776.00

Alfanumerička tipkovnica; pokretanje pritiskom na jedan gumb. Zaštita od defibrilacije. Program tumačenja rezultata i analize (za djecu i odrasle). Napajanje kroz el. mrežu ili rad na bateriju ( radni kapacitet 280 snimaka ili 6 sati praćenja).
Tehničke karakteristike:
• Način rada: automatski, ručni i ritam
• Ispis na termalni pisač visoke rezolucije, 110 x 144 mm papir Z preklop
• Memorija: pohrana 200 EKG snimaka.
• Ugrađeni filteri: AC, EMG, DFT
• Priključci: USB, čitač kartica, LAN ili serijski priključak (dodatan program)
• Vrlo izdržljiv uređaj s niskom stopom devijacije.
• Parametri mjerenja: HRV, RR interval
• Dimenzije: 322x310x101 mm.
• Težina: 3kg.
Šifra papira: 01.4.5791.00

01.1.5799.00 EKG stalak
01.1.5799.01 Držač kabela
01.1.5799.02 Košara za za EKG stalak
Za bolju ravnotežu i stabilnost prilikom korištenja EKG monitora i izuzetno stabilan. Postoje dva razmaka između kotača za lakše i sigurnije prebacivanje. Posjeduje dvije košare za odlaganje odgovarajućih medicinskih proizvoda, a visina mu se može podesiti između 58 i 109 cm. EKG se može postaviti s nagibom od 15 stupnjeva. Kompatibilan sa serijom SE.



Holter EKG-a s uključenim PC programom
Šifra
35130-GIM
Ovaj holter EKG sustav dolazi s EKG snimačem i PC programskom podrškom. Moguće ga je spojiti na računalni sustav ili laserski printer. Snimač ima ugrađenu (internu) flash memoriju koja povećava kapaciteta memorije uređaja. Važno je napomenuti kako brzina uzorkovanja od 1000 detekcija u sekundi poboljšava kvalitetu prikaza valnog oblika.
Značajke:

• Windows softversko sučelje (moguće je odabrati sljedeće jezike - GB, IT, PL, PT, RU)
• brz i točan sustav analize
• poseban sustav uređivanja R točke
• savršena funkcija analize ST segmenta
• funkcija analize T vala svih kanala i grafikon trenda T vala
• pregled grafičkog trenda EKG-a
• sustav analize varijabilnosti srčanog ritma (HR), pruža redovite SDNN, SDANN, RMSSD, LF, HF, vremensku i frekvencijsku domenu
• QT analiza
• izravna EKG stimulacija izravno bez zasebnog kanala;
• funkcije VCG, VLP, TVCG, HRT, TWA
Snimač:
• 12-kanalno sinkronizirano snimanje EKG-a
• mali EKG snimač s OLED zaslonom u boji za prikaz EKG krivulje u stvarnom vremenu i pregled pohranjenih podataka.
• kapacitet do 2G
• mogućnost odabira brzine uzorkovanja, 200, 500 ili 1000 uzorkovanja / sekunda
• točnost uzorkovanja: 12 bita
• ugrađena FLASH memorija kako bi se spriječilo oštećenje kartice uslijed opetovanog umetanja i vađenja
• USB sučelje
• operativni sustav: Windows 98, 2000, XP, 7, 8, 10
Tehničke karakteristike:
Napon: 1mV±5%
Standardna osjetljivost: 10mm/mV±5%
Razina buke: 30µV
CMRR: 60dB
Frekvencija: 10Hz kao referentna točka, 0,5Hz ~ 55Hz; -3dB
Vremenska konstanta: >3.2s
Brzina skeniranja: 25mm/s±5%
Stalan polarizacijiski napon: ± 300mV
Minimalni mjerni signal: 50µV p-p
Interferencija između kanala: <0,5 mm
Sigurnosni tip proizvoda: tip B (interno napajanje)
Dimenzije: 111 (D) x 60 (Š) x 25 (V) mm
Neto težina: 105 g (bez baterije)
EKG kabel i torbica za EKG uređaj 35130-GIM
Šifra Opis
35131-GIM kabel
35184-GIM torbica

PCECG-500 Džepni EKG Monitor
EKG sa 6 i 12 izvoda.

Prijenosni, lagani i jednostavni EKG monitor. Omogućava prikupljanje, analizu, pohranu i prijenos 12-kanalnog EKG zapisa. U kombinaciji s Glasgow algoritmom pruža potpunu i trenutnu analizu. Opremljen funkcijom automatskog prepoznavanja i označavanja pacemakera. Jednostavan za korištenje, lagan i prijenosan. Težine je samo 250 g, veličine približno poput pametnog telefona. 6/12-kanalni zapis omogućuje istovremeni prijem i prikaz valova 6/12 kanala, kao i detekciju srčanog ritma te indikator lošeg kontakta elektroda.
Tehničke karakteristike:
• Metoda: detekcija vrh-vrh
• Opseg mjerenja: 30-300 bpm; ± 1 bpm
• Broj odvoda: sinkrona akvizicija i analiza 6/12 odvoda
• Osjetljivost: 2,5, 5, 10, 20 mm/mV; ± 5%
• Ulazna impedancija: ≥50 MΩ (10 Hz)
• Uzorak
- Brzina uzorkovanja: 2000 uzoraka/sek
- Načini uzorkovanja: prethodno uzorkovanje, uzorkovanje u stvarnom vremenu, periodično uzorkovanje, uzorkovanje okidačem
• CMRR (Common Mode Rejection Ratio): ≥100 dB (AC filter uključen)
• Frekvencijski odziv: 0,05 Hz - 150 Hz + 0,4 dB (-3,0 dB), 10 Hz
• Vremenska konstanta: ≥3,2 s
• Filteri
- AC filter: 50 Hz, 60 Hz, isključen
- EMG filter (za elektromiografiju): 25 Hz, 35 Hz, 45 Hz, isključen
- ADS (Anti-Drift System) filter: 0,05 Hz, 0,32 Hz, 0,67 Hz
- Lowpass filter**: 75 Hz, 100 Hz, 150 Hz, isključen
• Brzina zapisa: 5, 6,25, 10, 12,5, 25, 50 mm/s; ±3%
• Napajanje: ugrađena punjiva litij-ionska baterija, 3,8 V, 6000 mAh
• Vrijeme punjenja: 8 sati
• Zaslon: 4,46-inčni LCD zaslon u boji, osjetljiv na dodir, rezolucije 480x854 piksela
Jednokanalni EKG uređaj CMS80A
Jednokanalni EKG s 12 izvoda.

Namijenjen za neivazivno mjerenje i prikaz EKG krivulje kod odraslih pacijenata. Mali uređaj, jednostavan za korištenje. Koristi se u ambulantama i bolnicama te se zbog svoje kompaktnosti lako prenosi i pogodan je za korištenje bilo gdje.
Tehničke karakteristike:
• Automatski i ručni način rada.
• Grafički LCD zaslon rezolucije 160x 96 px.
• Ispis jednog kanala u realnom vremenu na termalni pisač.
• Brzina ispisa: 25-50 mm/s.
• Ugrađeni filteri: AC, EMG. Indikator prazne baterije.
• Dimenzije: 19x9x4 cm.
• Težina: 500g.
• Mogućnost povezivanja s čunalom (CD s PC programom).
• Dimenzije i težina: 134 × 74 × 17 mm; 250 g (s baterijom) Šifra papira: 01.4.1763.00

EKG uređaji s Glasgow algoritmom za interpretaciju EKG-a.
100 S, 6-kanalni, 12 izvoda |
01.1.5767.00
01.1.5768.00
Dim: 285x204x65 mm | Težina: 1,8 kg
200 S, 12-kanalni, 12 izvoda |
Dim: 396x290x80 mm | Težina: 2,6 kg
Tehničke karakteristike:
• Moguć rad na baterije ili spajanjem na strujnu mrežu.
• Zaštita od defibrilacije.
• Mogućnost spajanja putem USB-a.
• Način rada: automatski (12 izvoda), manualni (3/6 izvoda), stat (12 izvoda).
• Termalni pisač.
• Termalni papir u listovima.
• Unutarnja memorija: do 100 EKGova.
• Kapacitet baterije: više od 500 EKG-ova (5+ sati neprestanog rada)
• Moguć izvod podataka u PDF ili SCP formatu.
• Cjelovita alfanumerička tipkovnica.
• Tip baterije: NiMH.
• Način rada: kontinuirani

Šifra papira: 01.4.5776.00


Šifra papira: 01.4.5777.00

Šifra
01.4.0510.00
01.4.1316.00
01.4.3323.00
01.4.3084.00
01.4.3650.00
01.4.3578.00
01.4.5349.00
01.4.3985.00
01.4.5357.00
01.4.2537.00
01.4.2539.00 KENZ R 50x30R 50 mm x 30 m
01.4.1125.00 KENZ R 112R 112 mm x 25 m
01.4.3659.00 KENZ R 112 112 x 90 mm (250 listova)
01.4.1020.00 KENZ R 183 x 30R 183 mm x 30 m
01.4.4075.00 Heart-Screen 112/112C 112 mm x 20 m
01.4.0607.00 Heart-Copy 112 mm x 30 m
01.4.0643.00 Heart-Mirror 57 mm x 20 m
01.4.4238.00 Clinic 112 x 150 mm (300 listova)
01.4.2659.00
01.4.3838.00
01.4.3895.00
01.4.2052.00 ER65, Galaxy 110 x 100 mm (300 listova)
01.4.2379.00 ER35, Eco Simple 60 x 100 mm (300 listova)
01.4.1005.00 MR11, BR12, X-20 50 mm x 28 m
01.4.3278.00 Medicor ER31 110 mm x 30 m
01.4.1807.00 ER361, 362, ER32, BR31 130 mm x 30 m
SIEMENS
01.4.0002.00 Burdick EK10 50 mm x 46 m
01.4.5604.00 Cardiostat 31/31S 104 x 100 mm (300 listova)
01.4.0486.00 Burdick E-350 210 x 300 mm (200 listova)
01.4.1453.00 Sicard 740 210 x 300 mm (200 listova)
Šifra Dimenzije
01.4.2104.00 Alpha 1000 63 x 100 mm (300 listova)
01.4.1960.00 Alpha 600/600 AX 145 x 150 mm (400 listova)
SCHILLER
01.4.4226.00 Schiller AT 101 80 x 70 mm (300 listova)
01.4.1249.00 Schiller AT-1 90 x 90 mm (400 listova)
01.4.3643.00 Schiller AT-2 210 x 280 mm (215 listova)
01.4.1255.00 Schiller AT-3 70 x 100 mm (200 listova)
01.4.2358.00 Schiller AT-5 135 x 140 mm (178 listova)
01.4.3346.00 Schiller AT-6 145 x 100 mm (300 listova)
MORTARA-RANGONI
01.4.1536.00 ELI-50 50 x 70 mm (200 listova)
01.4.2307.00 ELI-100 (MAC PC) 108 mm x 23 m
01.4.4232.00 ELI-150 108 x 140 mm (200 listova)
01.4.5601.00 ELI-200 215 mm x 30 m
01.4.5432.00 ELI -230 210 mm x 30 m
01.4.4500.00 ELI-250 210 x 300 mm (250 listova)
Šifra
01.4.4129.00 Coromterics 4305 BAO 152 x 90 mm (150 listova)
01.3.5346.00 EDAN 4305 F9-G 152 x 90 mm (150 listova)
01.4.3283.00 HP M1911A 152 x 100 mm (150 listova)
01.4.2293.00 Gima 215 215 mm x 25 m
01.4.5585.00 CMS-800 G 112 x 100 mm (150 listova)
01.4.5770.00 EDAN F9-P 150 x 100 mm (150 listova)
01.4.5766.00 EDAN Cadence 112 x 90 mm (150 listova)
CAREWELL / CARDIOGIMA / CARDIORAPID
01.4.1730.00 Cardiette Handy 6 110 mm x 30 m
01.4.1299.00 K 111, AUTO 12/1 50 mmx 30 m
SIEMENS
01.4.0002.00 Burdick EK10 50 mm x 46 m
01.4.5604.00 Cardiostat 31/31S 104 x 100 mm (300 listova)
01.4.0486.00 Burdick E-350 210 x 300 mm (200 listova)
01.4.1453.00 Sicard 740 210 x 300 mm (200 listova)
01.4.0989.00 EK41 full grid 55 mm x 40 m
01.4.3282.00 EK53/56 130 x 135 mm (370 listova)
01.4.3281.00 Cardiosmart 210 x 295 mm (150 listova)
01.4.1956.00 Microsmart 90 x 90 mm (350 listova)
Univerzalna torba za EKG uređaje
Šifra
01.4.1275.00
Velika torba: 38x32x8,5 cm

Adapter za elektrode s drukerima
Šifra Boja
01.4.2471.01 crvena
01.4.2471.02 crna
01.4.2471.03 zelena
01.4.2471.04 žuta
01.4.2471.05 bijela
Adapter potreban za pripajanje elektroda s drukerima. Naručljivo po komadudostupno u pet različitih boja.


EKG elektrode za prsa, vakumske
Šifra Dimenzije
01.4.0360.00 Ø 24 m
01.4.1109.00 Ø 15 mm
01.4.1515.00 zamjenska gumena pumpica
01.4.0360.01 Ø 24 mm
01.4.1109.01 Ø 15 mm
Šifra
3M-2330 BS 3.2 × 2.2 cm 100
3M-2228 BS 4.0 x 3,3 cm 50
3M-2239 BS promjer 6 cm 50
Gumeni senzor za prsa
Šifra OPIS
01.4.0009.00 za odrasle
01.4.0010.00 za djecu
01.4.0014.00 elektroda

Premaz niklom
01.4.0360.01
01.4.1109.01
Gel za EKG uređaj
Šifra OPIS
01.4.0531.00 260 ml
01.4.1489.00 kanistar od 5l
01.4.4027.00 spremnik od 5 l
Komplet elektroda-štipaljki, 4 komada
Šifra OPIS
01.4.1353.00 za odrasle
01.4.0585.00 za djecu Šifra

Periferne elektrodeštipaljke AH (4 kom)

Elektroda za jednokratnu upotrebu
01.4.3370.00

Pakiranje: 100 kom.
Dimenzije: 4x3,6 cm.
Samoljepljiva elektroda za jednokratnu upotrebu ITALY za EKG i holtere.
Periferijske pločaste elektrode Gumeni pojas za ruke/noge

01.4.0771.00
Elektrode za EKG s ljepljivim gelom za brzi EKG.
Spužvaste elektrode s ljepljivim gelom, rendgenski vidljivi, za odrasle pacijente. Mogu se koristiti do tri dana od trenutka postavljanja. Za holter.
Elektrode od 3M Micropore trake su prozračne, fleksibilne i prilagodljive, ali nježne za kožu. Niska količina klorida u ljepljivom gelu smanjuje nadraženost kože. Za EKG i holter, za odrasle osobe.





Pacijent-kabel
Šifra OPIS
01.4.0034.00 Cardioline Delta
01.4.1806.00 Univerzalni, Contec, HeartScreen
01.4.0359.00 Burdick
01.4.5765.00 Schiller i Contec





Kontaktni sprej za EKG uređaj
Šifra OPIS
01.4.1247.03 250 ml
01.4.1247.01 punjenje tekućine za sprej 1 L
01.4.1247.02 punjenje tekućine za sprej 5 L


Lepu digitalna medicinska rješenja koriste napredne tehnologije za pružanje medicinskih usluga i zdravstvene skrbi putem interneta. Ovakav pristup omogućuje smanjenje troškova zdravstvene skrbi te udaljene konzultacije sa zdravstvenim djelatnicima, čime se smanjuje potreba za osobnim dolascima.

Lepu PC-303 Medicinski prijenosni višenamjenski monitor vitalnih znakova
Može mjeriti neinvazivni krvni tlak (NIBP), glukozu u krvi, SpO2 (zasićenost kisikom), EKG (elektrokardiogram), PR (puls) i temperaturu putem svog 4,3-inčnog LCD zaslona. Pogodan je za kućno korištenje, za liječnike, klinike, medicinske sestre, medicinske ustanove.


Lepu M12 medicinski nosivi Holter monitor, 3 kanala i dinamički 12-kanalni EKG
Lagan, kompaktan dizajn: manje od 50 g. Zaslon visoke razlučivosti. Prikaz valnog oblika u stvarnom vremenu. Simultana akvizicija s 12 odvoda. Ugrađena punjiva baterija, kontinuirano praćenje do 72 sata.
Lepu rješenja uključuju višenamjenske monitore vitalnih znakova, pulsne oksimetre, EKG monitore i višep parametarske monitore pacijenata. Kontinuirano ulažemo u istraživanje i razvoj kako bismo unaprijedili i optimizirali svoje proizvode.

Lepu Medical prijenosni komplet
Klasični komplet: vaga za mjerenje tjelesne masnoće, termometar, BP2 (EKG + mjerenje krvnog tlaka), mjerač glukoze, pulsni oksimetar, EKG flaste.
Bluetooth funkcija: svi proizvodi mogu se povezati s aplikacijom Vihealth putem Bluetootha.


Lepu O2Ring™ Kontinuirani prstenasti oksimetar za mjerenje kisika u prstu
Lepu O2ring™ kontinuirani prstenasti monitor kisika ima jedinstven, lagan i nosiv dizajn za kontinuirano praćenje SpO2, HR i PI. Pametna vibracija koju pokreće niska SpO2. Ugrađena punjiva baterija za korištenje preko noći.

Lepu NeoEKG tablet
Visoka brzina analize: Za automatsku analizu EKG-a u mirovanju potrebna je samo 1 sekunda. Podržava istovremeno snimanje i prikaz 9-kanalnih i 12-kanalnih valnih oblika, kao i detekciju srčanog ritma/otkucaja srca. Podržava 16 vrsta srčanih klasifikacija i 104 vrste EKG dijagnostičkih klasifikacija. Visoka stopa točnosti

Lepu Medical AiView V12/V10 prijenosni sveobuhvatni monitor
Visoko precizno mjerenje SpO2, pulsa, EKG-a, NIBP-a (neinvazivnog krvnog tlaka), tjelesne temperature i disanja. Podržava korištenje s centralnim nadzornim sustavom (CMS). Dostupan je HL7 protokol, pregled od kreveta do kreveta i 12-kanalni EKG.
Holter ABPM 06 mjerač krvnog tlaka
Šifra
01.2.3992.00
ABPM-06 je programabilan, tih, mali, lagani ambulantni mjerač krvnog tlaka. 24 ili 48 sati rada osiguravaju četiri AA baterije. Jedan set baterija može izvesti 300 mjerenja. Monitor može pohraniti 600 mjerenja u svoju nepromjenjivu memoriju na neograničeno vrijeme. Pacijent može pokrenuti hitno mjerenje, označiti događaje i postaviti poseban dan/noćni alarm pomoću tipke na uređaju. ABPM-06 automatski detektira standardne, velike i male Meditech manšete.
Tehničke karakteristike:

• Točna i pouzdana A/A validacija (algoritam potvrđen ESH-IP, BIHS i AAMI)
• Automatsko otkrivanje manžete, podesivi maksimalni tlak u manžeti
• SleepWell algoritam prilagođen pacijentu
• Ugrađeno snimanje glasa
• Napajanje: 2 AA baterije ili baterija
• Metoda mjerenja: oscilometrijska metoda, stepenasto rasterećenje tlaka, poluvodički senzor tlaka
• Raspon mjerenja: krvni tlak 30-280 mmHg, puls 40-240 / min
• Pasivna točnost: +/- 3Hgmm ili 2% izmjerene vrijednosti
• Prijenos podataka: standardni mini USB
• Dimenzije: 70 x 99 x 30 mm, težina: 196 g (bez baterija)
Card(X)plore kombinirani holter sustav mjerenja za krvni tlak i EKG
Šifra
Card(X)plore je idealan ambulantni uređaj za kompleksnu kardiovaskularnu dijagnostiku, s trokanalnim EKG-om te cjelokupnom opremom za mjerenje krvnog tlaka.
Tehničke karakteristike:

Holter tlaka s oksimetrom ContecABPM-PM50
Šifra
01.2.5754.00
Multifunkcionalni monitor za dugotrajno mjerenje SpO2 te neinvazivno mjerenje krvnog tlaka (NIBP). Kompaktan, prenosiv i jednostavan za uporabu. Za bolničku ili kućnu uporabu. Uređaj prilagođen potrebama korisnika.
Tehničke karakteristike:


Ugrađen senzor SpO2 i standardna manžeta. Dvojni način rada; funkcija praćenja i 24-satni holter za neinvazivno mjerenje krvnog tlaka. Visokokapacitetno snimanje podataka za NIBP i SpO2. Jednostavno radno sučelje: korisnik može vidjeti traku s izbornicima i pregledati rezultate mjerenja. Zvučni i svjetlosni alarm koji upozorava na slabo napajanje, pogreške u podacima i proteklo vrijeme . Postavke alarma, fleksibilno konfiguriranje podataka o pacijentu.
Sve podatke možete prenijeti na osobno računalo preko softvera za OS Windows (na engleskom jeziku) te ih pregledavati i ispisati . Napajanje: 2 »AA« alkalne baterije (nisu uključene)
Holter tlaka Contec - ABPM-50
Šifra
01.2.0901.00
Uređaj za praćenje krvnog tlaka za vrijeme obavljanja svakodnevnih aktivnosti. Kompaktan, prenosiv, jednostavan za korištenje. Sučelje prilagođeno korisniku. Prikladan za primjenu kod odraslih, pedijatrijskih i neonatalnih pacijenata. Neinvazivno mjerenje krvnog tlaka tijekom 24 sata.
Tehničke karakteristike:

Do 51 sat neprekidnog rada s potpunom funkcionalnošću EKG-a, ambulatornog mjerenja krvnog tlaka prikaz vizualnog grafikona u dvije osi. Pohranjivanje podataka na SD karticu. Kontinuirana analiza EKG-a, s neometanim mjerenjem neovisno i razini kretanja. Fleksibilno programiranje EKG tijekom mjerenja. Visokokvalitetne elektrode. Podešavanje postavki alarma, obavijesti, označivanja događaja, automatsko prepoznavanje manžete, prikaz voltaže i stanja baterije.
Manžete za holtere Contec
01.2.5759.00 Šifra OPIS

01.2.5750.03 Standardna
01.2.5750.01 Velika
01.2.5750.02 Dječja
01.2.5750.05 Za bebe
ABPM mod može snimiti do 350 rezultata mjerenja, ručnim mjerenjem može se memorirati do 300 rezultata. TFT LCD zaslon visoke rezolucije od 2,4’’ pruža izvrsnu jasnoću slike i prikazuje upozorenja o razini napunjenosti baterije, alarm, pogreške i vrijeme. Mjerne jedinice: mmHg / kPa. Komunikacija s osobnim računalom omogućava pregled podataka, analizu rezultata mjerenja, graf tendencija, ispis izvještaja i druge funkcije. Način mjerenja: oscilometrijska metoda, na nadlaktici. Interval mjerenja: 15, 30, 0, 10, 240 minuta. Alarm: SYS/DIA. Napajanje: 2 »AA« alkalne baterije (nisu uključene). Dimenzije: 128×69×36 mm. Težina: 350 g
Manžete i dodaci za Meditech holtere
01.2.5750.04 Za novorođenčad Šifra OPIS
01.2.1530.01 Velika manžeta
01.2.1530.02 Dječja manžeta
01.2.1530.03 Standardna manžeta
01.2.2378.00 Torbica za holter

Pouzdanost mjerenja, značajke dijagnostike i jednostavnost rada su pretpostavke za primjenu BTL CPET sustava u raznim medicinskim ustanovama. Bez obzira radi li se o procjenama napretka treninga ili dijagnostike intolerancije na vježbu, BTL’s CPET sustav osigurava ispitivaču pouzdane rezultate, prikazane na modernom i jednostavnom korisničkom sučelju. BTL test opterećenja osigurava sve uvjete za sigurnu i ispravnu provedbu pretrage. Većina funkcija je automatizirana, što rezultira uštedom vremena i olakšava dijagnostički postupak. Šifra
BTL-CPET-TRA
BTL-CPET-BIC
BTL-STRES-TRA
BTL-STRES-BIC

BTL-CPET-TRA - kardiopulmonalni test - traka

BTL-STRES-TRA - stres test traka


BTL-CPET-BIC - kardiopulmonalni test opterećenja - bicikl

BTL-STRES-BIC - stres test bicikl


Cardioline XR50 + bicikl ergometar / 67019357 XR50
Ergometar Bicikl CHRONO PRO - LINEBRX3000 Šifra
01.1.4105.00
Ergometar s dvostrukim zaslonom za teške uvjete rada.
Tehničke karakteristike:
• Otpor opterećenja može se podesiti između 6-450W
• Podešavanje brzine između 30130 o/min
• Maksimalna nosivost 160 kg
• Zaslon 68x34mm i 128x64mm
• Računalno upravljani elektronički kočioni sustav koji je neovisan o brzini, tako da u svakom trenutku održava zadano opterećenje.
• Komunikacija: USB port, RS232 port, daljinski upravljač
• Veličina: 1000x440x1280 mm
• Težina: 55 kg

Ergometar s modulom za mjerenje krvnog tlaka LODE
01.1.1122.00
01.1.4104.00
Tehničke karakteristike:
• Kontinuirano opterećenje: 7-750 W.
• Najviše opterećenje (max. 6 min.): 1000 vata; povećavanje opterećenja u koracima od 1 W, točnost opterećenja <100 W ± 3 W.
• Broj okretaja: 30 - 150, kontrola opterećenja: hiperbolična, linearna, pomoću fiksnog momenta sile i na temelju otkucaja srca.
• Kalibriranje: dinamičko.
• Načini rada: ručni, analogni, terminalni.

• Podešavanje visine sjedala: u rasponu od 300 mm, minimalna dužina noge korisnika: 645 mm, raspon podešavanja upravljača: 360°
• LCD, 2×16 znakova; podesive postavke.
• Maksimalna težina korisnika: 160 kg
• Dimenzije: 115×60×114 cm
• Težina: 52 kg
01.1.1122.00 - Ergometar s modulom za mjerenje krvnog tlaka LODE
01.1.4104.00 - Ergometar LODE Corival
Ergometar s indukcijskim magnetskim sustavom kočenja, elektronsko podešavanje otpora - 32 stupnja. Težina zamašnjaka - 16 kg, Nosivost - 160 kg. Funkcije: mjerenje brzine, pulsa, udaljenosti, vremena, kalorija, okretaji po minuti
Tehničke karakteristike:
• Poluga pedale - trodijelna
• Pedale - ekstra velike s remenom
• Težina - 52 kg
• Dimenzije - 960 x 560 x 1430 mm
• Bruto težina - 58 kg

• Veličina pakiranja - 1000 x 275 x 680 mm
• Certifikat - CE-ROHS-EN957 - S (Studio) class








Traka za trčanje XR450
XR450 je traka za trčanje s nizom tehničkih inovacija što ju čini pogodnom pogodnom i izuzetno sigurnom za sve uzraste. Primjenom novih tehnologija i materijala znatno su smanjeni štetni učinci na zglobove, posebno koljena i gležnjeve, te je smanjeno naprezanje u donjem dijelu leđa. Gazište je stabilno i ugodno za trkača/pacijenta.
Tehničke karakteristike:
• Dimenzije: 70 x 188 x 142 cm
• Težina: 145 kg
• Brzina: 0,1 do 20 km / h. Nagib: 0-22%
• Površina za trčanje: 140 x 48 cm
• Snaga: 5 KS
• Napon: 220V 10A Zahtjevi
• Buka: 30 dB manje od
• Maksimalno opterećenje (težina pacijenta): 150 kg
• Priključak: serijski port (RS232)
• Komunikacijski protokol: Trackmaster

Monitor vitalnih funkcija EDAN X10
Šifra
01.3.5407.00
Edan X10 je premijerni monitor za pacijente u liniji X-serije, koji se može koristiti u svim okruženjima uključujući hitne službe, rehabilitacijske centre i ICU. 3/5 EKG, RESP, NIBP, Edan SpO2, TEMPERATURA, PULS, AKUMULATOR, ekran osjetljiv na dodir, pisač
Tehničke karakteristike:
• Glavna jedinica, 10-inčni zaslon, bez ventilatora, pisač
• EKG od 3/5-odvoda, RESP, NIBP, Edan SpO2, 1-TEMP, PR
• Aritmije, ST analiza, OxyCRG, Veliki font, Vital Display
• 200 memorije alarmnih / ARR događaja
• 1 20-satni grafički i tablični trendovi svih parametara
• USB pohrana podataka i pregled
• Dv osmjerna komunikacije sa središnjim sustavom nadzora
• Podesiva boja valnog oblika
• Prilagođene postavke alarma


• Opcije: 6/12-lead EKG, IBP, EDAN G2 CO2 (Sidestream), ugrađeni Wi-Fi, ugrađena SD kartica, zaslon osjetljiv na dodir, poziv medicinske sestre, defibrilator, sučelje za sinkronizaciju
Monitor vitalnih funkcija EDAN X8
Šifra
01.3.5406.00
Edan X8 se može koristiti u svim okruženjima uključujući hitne službe, rehabilitacijske centre i ICU. 3/5 EKG, RESP, NIBP, Edan SpO2, TEMPERATURA, PULS, AKUMULATOR
Tehničke karakteristike:
• Glavna jedinica, 8-inčni zaslon, bez ventilatora
• EKG od 3/5-odvoda, RESP, NIBP, Edan SpO2, 1-TEMP, PR

• Aritmije, ST analiza, OxyCRG, Veliki font, Vital Display
• 200 memorije alarmnih / ARR događaja
• 120-satni grafički i tablični trendovi svih parametara
• USB pohrana podataka i pregled
• Dvosmjerna komunikacije sa središnjim sustavom nadzora
• Podesiva boja valnog oblika
• Prilagođene postavke alarma
• Opcije: 6/12-lead EKG, EDAN G2 CO2 (Sidestream), ugrađeni Wi-Fi, ugrađena SD kartica, zaslon osjetljiv na dodir, VGA / poziv medicinske sestre / analogni izlaz / defibrilator, sučelje za sinkronizaciju, pisač
Monitor vitalnih funkcija CMS8000
Šifra
01.3.0918.00
01.3.0918.01
Način prikaza: TFT LCD zaslon visoke rezolucije od 12’’ u boji. Može se koristiti za potpuno praćenje odraslih, djece i novorođenčadi. Jezici prikaza su kineski i engleski. (Dostupni jezici: francuski, njemački, talijanski, nizozemski, turski, itd.). Postoji nekoliko načina prikaza koje možete izabrati, kao što je prikaz velikih znakova. Valni oblik i boja podataka mogu se postaviti. Memorija: pohranite i pregledajte 480 sati podataka o trendu i 40-sekundni holografski valni oblik. Zaslon prikazuje 7-odvodni EKG i niz EKG tragova. Anti-visokofrekventni kirurški uređaj, otporan na defibrilator (zadovoljava različite posebne zahtjeve).


Koristi digitalnu Spo2 tehnologiju, koja ima snažnu zaštitu od smetnji i nisku sposobnost punjenja.
Tehničke karakteristike:
400 NIBP podataka može se pohraniti i pregledati. Umrežno : spojivo na središnju stanicu, druge nadzirane krevete i ažuriranje softvera. Način mrežnog povezivanja: žičane i bežične. Ugrađena SD kartica. U disk za pohranjivanje podataka i U disk za ažuriranje. Izlaz za podršku VGA video značajkama i podesivim LCD pozadinskim osvjetljenjem. Alarm s ljudskim glasom. Funkcija simultanog izlaza signala. Tri načina rada: praćenje, operacija i dijagnostika. Automatska analiza valnog oblika aritmije. Proračun koncentracije lijeka i titracija. Dvokanalna provjera temperature i signal u slučaju temperaturne greške. NIBP softver i hardver za dvostruku zaštitu od nadtlaka. Ugrađena punjiva litijska baterija za kontinuirano praćenje. Uređaj ima američki FDA i europski CE certifikat. Standardni parametri: EKG SPO2 NIBP RESP TEMP PR. Dodatni parametri: 2-IBP CO2. Sadržaj paketa: 1 - pinceta sPO2 za odrasle - EKG kabel - NIBP manžeta + produžna cijev - Kabel za napajanje - Senzor temperature - EKG elektrode - Baterija 01.3.0918.01 | s termalnim pisačem
Šifra
01.3.5376.00
Monitor vitalnih funkcija, namijenjen za upotrebu kod odraslih pacijenata, djece i novorođenčadi. Izvrstan uređaj, veoma jednostavan za korištenje.
Tehničke karakteristike:
Primjena: Kirurgija, intenzivna njega, hitna služba, opstetricija i ginekologija, pedijatrija. Ugrađena Litij-polimer baterija za sigurnije praćenje. Kompaktan i lagan dizajn. Uređaj je prenosiv, te je tako prikladan za korištenje na terenu te u zatvorenom prostoru. Shvatljivo i jednostavno korisničko sučelje. Zaslon: 2.8” (320x240px) LCD u boji, s crvenim i žutim LED. Motri sistolički (SYS) i dijastolički (DIA) krvni tlak, SpO2 i puls. Moguće podešavanje graničnih vrijednosti. Flash memorija, pohranjivanje 2.000 NIBP unosa i 78.000 SpO2 unosa. Prikladno i brzo dohvaćanje podataka, NIBP, SpO2, PR moduli.


Monitor vitalnih funkcija M3A SpO2 + NIBP s 2 zaslona (3,5” LCD zaslon u boji i LED zaslon u boji). Namijenjen za upotrebu u bolnici i kod kuće. Prijenosan, s 1 litijskom baterijom. Vrijeme rada 240 min, vrijeme punjenja 180 min.
Tehničke karakteristike:
72h unutarnje memorije. 5 sati memorije za SpO2 krivulju, 2,5 sata za SpO2+CO2 krivulju. Prikaz 30.000 NIBP mjerenja i 800 alarma. Opcionalan printer. Uključeni dodaci: SpO2 senzor za odrasle. Dimenzije: 174(d) x 189(š) x 235(v) mm. 3,5kg (bez baterija).
Monitor vitalnih funkcija Moretti

TFT LCD zaslon u boji visoke razlučivosti, veličine 10,1”. Prikaz mjernih parametara: EKG, RESP, SpO2, NIB, PR, 2-TEMP. Namijenjeno za odrasle, pedijatrijske i neonatalne pacijente. Analiza aritmije. Detekcija pacemakera, zaštita od smetnji pri defibrilaciji i elekrokirurgiji. Prikazani tragovi: do 8. Prikazani valni oblici: do 11. Brzina izmjene: 6,25, 12,5, 25, 50 mm/s. Vrsta kanala: 5 izvoda i 3 izvoda (odabir). Memorija: graf trendova za 96 sati, 500 NIBP mjerenja i 60 alarma. USB priključak. Dolazi s ručicom za transport. Ugrađen printer (opcionalno).
Dodaci koji dolaze uz uređaj:
• 1 EKG kabel s 5 izvoda, štipaljka, defib, IEC, 3.5m, višekratni
• 30 EKG elektroda, za odrasle, jednokratne
• 1 SpO2 senzor za prst, odrasli, 2.5m, višekratni
• 1 NIBP manžeta, odrasli, 25cm - 35 cm, višekratna
• 1 NIBP cijev, 3m
• 1 sonda za temperaturu na koži, odrasli, 3m, višekratna
• 1 kabel za napajanje (EUR standard)
• 1 punjiva litij-ionska baterija (14.8V, 2100mAh)
• 1 kabel za uzemljenje

7-inčni TFT LCD zaslon visoke rezolucije. Lagan, kompaktan i prenosiv uređaj inovativnog dizajna.
• Funkcije: EKG, mjerenje broja udisaja (RESP), neinvazivno mjerenje krvnog tlaka (NIBP), zasićenost krvi kisikom (SpO2), temperatura (TEMP), puls (PR).
• Zvučni i vizualni alarm.

• Memorija: 256 sati snimljenih podataka Digitalno podešavanje jačine zvuka. Napajanje. AC-DC adapter.
• Rad na bateriju: više od 2 sata.
• Ugrađena punjiva litij-ionska baterija.
• 2-kanalni prikaz mjerenja temperature.
• Opcije: invazivno (intraarterijsko) mjerenje krvnog tlaka (IBP), ETCO2, ugrađen pisač.

S 2.8” LED i LCD zaslonom.

• Namijenjeno za odrasle i dječje pacijente. Do 99 pacijenata s ID-om i 72-satnim podacima snimanja; 3 razine zvučnog alarma, dodatni senzori i opcionalno snimanje u stvarnom vremenu.
• Prikazani parametri: PR, PI, puls, val, SpO2 pletizogram, NIBP (SYS, DIA, MAP).
• Odvojen prikaz sistoličkog i dijastoličkog tlaka. Prijenos podataka na računalo putem USB porta.
• SpO2 raspon mjerenja: 70%-100%
• Puls raspon mjerenja: 30-250 bpm
• PI raspon mjerenja: 0,2%-20%
• Dim: 296(d) x 175(š) x 96(v) mm
• Težina: 1,5 kg s baterijom
Manžete za mjerenje tlaka
Za odrasle, srednja
Za novorođenčad


Šifra
IMAC-M70
Model M70 koristi Seed-ovu vrhunsku tehnologiju i algoritam za obradu slike. Ovaj visoko integrirani uređaj kombinira izvrsnu kvalitetu slike, sveobuhvatne funkcije, učinkovit radni tijek i prikladnu mobilnost u jedan aparat, omogućujući dvostruku upotrebu (koristi se kao stolni ili kao prijenosni uređaj). M70 je jednostavan za upotrebu u ultrazvučnim odjelima te idealan za mobilne dijagnostičke i terapijske primjene.

Napredne tehnologije prikaza
• Prostorni slojeviti prikaz (Spatial Composite Imaging)
• Frekventno slojeviti prikaz (Frequency Composite Imaging)
• Inverzno harmonijski prikaz pulsa (Pulse Inverse Harmonic Imaging)
• Inteligentni prikaz kompenzacijom brzine zvuka
• Kolor panoramski prikaz u stvarnom vremenu (Real-time Color Panoramic Imaging)
• Prikaz mikroprotoka (zMicroflow)
• Trapezoidni prikaz (Trapezoidal Extension Imaging)
• B/C/D povezani prikaz (B/C/D Linkage Imaging)
• Inteligentni 3D/4D prikaz
Učinkovita kontrola | Izvanredno iskustvo
• Redukcija šuma na slici (Speckle Noise Reduction Imaging)
• Poboljšanje igle iz više kutova
• Automatsko mjerenje karotidnog IMT-a
• Automatska spektralna ovojnica
• 15,6’’ medicinski LCD monitor visoke rezolucije, podesivog kuta
• 3 aktivna priključka za sonde
• Ugrađena litijska baterija
Kompaktni Color
Doppler UZV - ViV 20
IMAC-VIV20
Ergonomski Dizajn. Kombinacija ergonomskog dizajna i kompaktnih dimenzija, ViV 20 nudi izuzetnu prilagodljivost koja omogućuje primjenu u različitim kliničkim scenarijima.
• 21,5” medicinski LCD zaslon
• Podesiv kut
• Preklopiv
• 13,3” zaslon osjetljiv na dodir visoke osjetljivosti
• Podesiv kut
• Optimizirano TGC područje (Time Gain Compensation)
• TGC kontrola smještena s lijeve strane za lakše upravljanje.
• 4 univerzalna priključka za sond
• Upravljanje kabelima
Tehnologije

• Pulse Inverse Harmonic Imaging (PIHI)
• ZClear - Tehnologija redukcije šuma (SRI)
• Spatial Compound Imaging (SCI)
• ZLive
• ZPage
• EFOV - Prošireno vidno polje
• Tissue Specific Imaging (TSI)
• Panoramski prikaz
Kompaktni Color Doppler OB-GYN UZVViV 40
IMAC-VIV40
ViV 40 nudi izuzetnu prilagodljivost, zahvaljujući izvrsnom ergonomskom dizajnu i kompaktnoj veličini, što ga čini pogodnim za različite kliničke potrebe.
• 21,5” medicinski LCD zaslon
• Podesiv kut
• Preklopiv
• 13,3” zaslon osjetljiv na dodir visoke osjetljivosti
• Podesiv kut
• Optimizirani kontrolni panel
• Podesiva visina (motorizirana)
• Podesiv kut
• Optimizirano TGC područje (Time Gain Compensation)
• TGC kontrola smještena s lijeve strane za lakše upravljanje.
• 4 univerzalna priključka za sond
• Upravljanje kabelima
• uSeed Platforma

• Obstetrija i Ginekologija
• ZLive
• ZPage
• EFOV - Prošireno vidno polje
Specifikacija osnovnog uređaja:
• LED zaslon u boji 21,5’’
• Zaslon osjetljiv na dodir (13.3’’, tanak, lako podesiv pod kutevima, podržani su pokreti na dodir)
• Revolucionarna ZST+ platforma
• Četiri konektora za sonde
• Lako prilagođavanje položaja upravljačke ploče
• B/M/PW/HPRF/Color/Color M/Power/Usmjereni Power Doppler, HD Scope, iClear (umanjenje artefakata)
• Napredni alati za poboljšanja slike: iBeam™ (prostorna obrada slike), iTouch™ (automatska optimizacija slike), iCompare (multimodalitetno uspoređivanje slika), Odmagljivanje, Echo Boost, 3D iClear, Depth VR, ZOOM, HR Flow (sitna vaskularizacija)
• Ostalo: MedTouch™, MedSight™, iStation™ upravljanje podacima pacijenata, iScanHelper (funkcija Tutorial), Hard disk (1TB), HDMI, USB 3.0 port, Držač za endokavitalnu sondu, Ugrađeni wi-fi adapter, Smart Vue, Smart Calc Paket osnovnih softverskih alata:
• DICOM Basic - ispis i funkcija DICOM pohrane, DICOM radna lista
• Paketi usluga - opstetricija, pedijatrija, ginekologija, abdomen, urologija, mali organi, krvne žile, živci, hitna medicina i kardiološki paket Paket naprednih sofverskih alata:
• iScape View - panoramsko snimanje u realnom vremenu, Strain Elastography - Elastografija Natural Touch, Smart 3D - 3D freehand, iNeedle - poboljšavanje vizualizacije igle, IMTautomatsko mjerenje IMT-a, Smart Hip - automatsko mjerenje kukova u pedijatriji, Smart Bladder - automatsko izračunavanje volumena mjehura, iWorks - Standardizirani protokol tijeka rada, DVR Module – alat za snimanje zvuka i zaslona, ClamAV – antivirusni program

3C5A konveksna abdominalna sonda
L13-3 linearna sonda
Specifikacija osnovnog uređaja:
• LED zaslon u boji 21,5’’
• Zaslon osjetljiv na dodir (15.6’’, tanak, lako podesiv pod kutevima, podržani su pokreti na dodir)
• Revolucionarna ZST+ platforma
• Pet konektora za sonde
• Lako prilagođavanje položaja upravljačke ploče
• B/M/PW/HPRF/Color/Color M/Power/Usmjereni Power Doppler, HD Scope, iClear+ (umanjenje artefakata)
• Napredni alati poboljšanja slike: iBeam™ (prostorna obrada slike), iTouch™ (automatska optimizacija slike), iZoom™ (prikaz preko cijelog zaslona), iCompare (multimodalitetno uspoređivanje slika), Odmagljivanje, Echo Boost, 3D iClear, Depth VR, ZOOM, HR Flow (sitna vaskularizacija)
• Ostalo: MedTouch™, MedSight™, iStation™ upravljanje podacima pacijenata, iScanHelper (funkcija Tutorial), Hybrid Hard disk (1TB), HDMI, USB 3.0 port i c-utor, Držač za endokavitalnu sondu, Višejezična tipkovnica, Ugrađeni wi-fi adapter, Grijač gela, Smart Vue, Smart Calc Paket osnovnih softverskih alata:
• DICOM Basic - ispis i funkcija DICOM pohrane, DICOM radna lista
• Paketi usluga - opstetricija, pedijatrija, ginekologija, abdomen, urologija, mali organi, krvne žile, živci, hitna medicina i kardiološki paket Paket naprednih sofverskih alata:
• iScape View - panoramsko snimanje u realnom vremenu, Strain Elastography - Elastografija Natural Touch, Smart 3D - 3D freehand, Glazing Flow - inovativna 3D vizualizacija 2D boje/ protoka, iNeedle - poboljšavanje vizualizacije igle, IMT - automatsko mjerenje IMT-a, Smart Hip - automatsko mjerenje kukova u pedijatriji, iWorks - Standardizirani protokol tijeka rada, DVR Module – alat za snimanje zvuka i zaslona, ClamAV – antivirusni program

Šifra OPIS
C5-1 konveksna abdominalna sonda
L13-3N linearna sonda
Ultrazvučni uređaj EDAN U50
Šifra
01.5.5719.00
Jednostavan za korištenje i s vrlo jasnom slikom na ekranu. Njegova kompaktna veličina čini ga jednostavnim za prijenos i izuzetno mobilnim. Ovaj uređaj odlikuje i najbolji odnos kvalitete - cijene u ovom razredu ultrazvučnih jedinica. Područja primjene: interna medicina, opstetricije - ginekologija, urologija, kardiologija, pregled zglobova i mekog tkiva, vaskularna kirurgija, reumatologija, anesteziologija.
Tehničke karakteristike:

Dostupno 8 različitih glava (Convex C352UB, Micro-convex C6152UB, Micro-convex C612UB, Micro-convex C422UB, Linear L742UB, Linear L1042UB, Linear L552UB, Transvaginal E612UB) različitih veličina i frekvencija. Načini rada: B, 2B, 4B, M, Color Doppler, Power Doppler, Power Doppler vođeni, spektralni Doppler. 12,1 LCD zaslon rezolucije: 1024 × 768. Doppler: Boja, PDI / DPDI, PW, CW, HPRF. Faza Harmonic Imaging. Multi-Beam Imaging. Smanjenje zrnatosti slike. SCI: postupak trodimenzionalnog prikaza slike. Izbornik 10 jezika. Alfanumerička tipkovnica. Siva skala: 256. Cine loop memorija: 1,227 slika. Dubina analize: 19-127 mm. Formati za pohranu slika: BMP, JPG, PDF, AVI, CIN, FRM, DCM. Priključci: dvije glave, dva USB, S-Video, Ethernet (DICOM), VGA, nožni prekidač. Opcije: videoprinter, kolica, 500GB HDD. Težina: 7,8 kg.
Ultrazvučni uređaj s kolicima EDAN U2
Šifra
01.5.5734.00
Praktičan ulltrazvučni uređaj s Color Dopplerom odgovara potrebama liječnika i specijalista Područja primjene: opstetricija i ginekologija, interna medicina, pregled mekog tkiva, pregled krvnih žila, urologija, kardiologija i pedijatrija.
Tehničke karakteristike:
15’’ LCD zaslon, 1024x768px. Priključka za 4 sonde. Doppler: PW color doppler, PDI (power doppler imaging), DPDI ( directional power doppler imaging). Način rada: B, B+B, 4B, B+M, M,B+PDI/ DPDI i B+PDI DPDI/ +PW. Najviša frekvencija od 14,8 MHZ Ugrađena litijum-ionska baterija. 500 MB interne memorije za pohranu podataka. Optimizacija slika: eHCI (Phased inversion harmonic compound imaging), mBeam (multi beam forming), eSRI (Specke Resistance Imaging), SCI (Spatial Compounding Imaging). Optimizacija slike jednim dodirom (prema unaprijed postavljenim postavkama). Priključci: VGA, kompozitni video ulaz, USB. Uz uređaj nisu uključene sonde.
Ultrazvučni uređaj s konveksnom sondom EDAN DUS 60
Šifra
01.5.5733.00
Visokokvalitetni prijenosni, crno-bijeli ultrazvučni skener s PW doplerom. Područja primjene: interna medicina, opstetricija i ginekologija, urologija, pregled zglobova, kardiologija, biopsija i druga područja koja zahtjevaju PW, no ne i color doppler.
Tehničke karakteristike:

12,1’’ TFT LCD zaslon; Istovremeno priključivanje dvije sonde; Najviša frekvencija do 10 MHz. Funkcije: THI (Tissue Harmonic Imaging) i TSI (Tissue Specific Imaging); Ugrađena litijum-ionska baterija; Siva skala: 256 nijansi; Cine Loop memorija; 500 MB interne memorije za pohranu podataka; Sonda: konveksna (1 kom); Zoom: 1x - 4x, panoramski zoom; Automatska optimizacija slike; Optimizacija slike jednim dodirom (prema unaprijed postavljenim postavkama). Dodatne opcije: DICOM 3.0, videopisač, prijenosni stalak, back-up velikog kapaciteta, torba Uključeni dodaci: LDR810 - konveksna sonda (2.5/3.4/4.5/H2.5/ H2.7MHz); 2 osigurača; Držač za UZV gel; UZV gel 250g; Kabel za napajanje (EUR standard); Kabel za uzemljenje; Nosač pretvarača; Potporni kabelski priključak; Flash Disk (Netac, 2G, USB2.0 protokol).
Nožni prekidač za EDAN DUS 60

Šifra LDR830

Ultrazvučni uređaj Welld WED180 s konveksnom sondom 3,5 MHz
Šifra
01.5.5740.00
Područja primjene: interna medicina, opstetricije - ginekologija, urologija, kardiologija, pregled mekog tkiva, staničnih čestica i kardiovaskularnog sustava. Upravljanje mikro-računalom, koristi DSC, DBF, RDA (Real-time dynamic aperture). Visokokvalitetan i stabilan prikaz u visokoj rezoluciji.

Tehničke karakteristike: Priključci: linearna sonda i konveksna sonda. Istovremeno se mogu priključiti 2 sonde. Dubina analize: 250 mm (max.). Parametri za podešavanje slike: crno / bijelo; lijevo/desno, gore / dolje; svjetlina, zasićenje, dinamički raspon, žarišna duljina, položajfokusa, korelacija slike, brzina i jačina zvuka. Snimanje: Faza Harmonic Imaging. Smanjenje zrnatosti slike. Gama korekcija, histogram i pseudo-snimanje. Mjerenje: udaljenost, opseg, područje, volumen, srce, GA, EDD, FW Automatska izrada nalaza.
Ultrazvučne sonde
Ultrazvučni odašiljači, tzv. sonde, su uređaji koji odašilju ultrazvučne valove koji se odbijaju od tjelesnog tkiva te tako stvaraju jeku, koju sonda onda prikuplja kao podatke koje šalje u računalo, koje valove pretvara u sliku koja se naziva sonogram. Sonde su iznimno bitan dio svih ultrazvučnih uređaja budući da su ključni instrument za izradu slike temeljene primljenim ultrazvučnim signalima. Isto tako, o njima izravno ovisi i kvaliteta dobivene slike. Postoji nekoliko vrsta sondi, od kojih su najčešće linearne i konveksne (te mikrokonveksne), te endovaginalne i endorektalne sonde.
Linearna sonda
Raspored piezoelektričnih kristala u ovim sondama je linearan, zbog čega je snop valova pravokutan. Ove sonde imaju širok otisak, a središnja frekvencija je između 2,5 Mhz i 12 Mhz. Koriste se za razne namjene poput vaskularnih pregleda, prikaza krvnih žila, pregleda dojki, štitnjače i tetiva, laparoskopije, mjerenja debljine masnog tkiva i mišića pri sistematskom pregledu te za fotoakustične prikaze.
Sonde za ultrazvučni uređaj EDAN U50 i EDAN U2
Šifra OPIS
01.5.5720.01
Convex C352UB (2.5 / 3 .5 / 4.5 / H2.5 / H2.7MHz)
01.5.5720.02 Micro-convex C6152UB (5.5 / 6.5 / 7.5 / H4.5 / H4.7MHz)
01.5.5720.03 Micro-convex C612UB (5.5 / 6.5 / 7.5 / H4.5 / H4.7MHz)
01.5.5720.06 Linear L1042UB (8 / 9.5 / 11 / H6.5 / H 6.7MHz)
01.5.5720.07 Linear L552UB ((4.5 / 5.5 / 6.5 / H2.8 / H 3.0MHz)
01.5.5720.08 Transvaginal E612UB (5.5 / 6.5 / 7.5 / H4.5 / H4.7MHz)
01.5.5720.09 Phase-array P5-1b (2.0/2.5/3.0/ H4.0/H5.0 MHz, 64 elemenata)




Gel za ultrazvuk
Šifra OPIS
01.5.0567.00 260 ml
01.5.1296.00 5 L kanistar
01.5.4028.00 5 L spremnik
01.5.2429.00 10 L kanistar
01.5.4067.00 260 ml s aloe verom
01.5.4256.00 5 L kan.s aloe verom
01.4.1954.01 pumpa za kan. 5 L
01.4.1954.02 pumpa za kan. 10 L




Medicinski kondomi - navlake za sondu
Šifra OPIS
10.0.3735.00 34 mm, s lubrikatnom, 1 kom
10.0.3641.00 28 mm, suhi, 144 kom
10.0.1412.00 34 mm, suhi, 200 kom
Konveksna sonda
Ove sonde se nazivaju i zakrivljenima zbog činjenice da su piezoelektrični kristali postavljeni u zakrivljenoj liniji. Ovaj tip sonde je idealan za preglede koji zahtijevaju dublji prodor u tkivo, premda se bistrina slike pogoršava što je prodiranje dublje. Središnja frekvencija ovakvih sondi je obično između 2,5 mHz i 7,5 Mhz. Koriste se za preglede abdomena, transvaginalne i transrektalne preglede te za dijagnostiku organa.
Mikrokonveksna sonda
Ova sonda u suštini spada pod kategoriju konveksnih sondi, no ima manji raspon dostupne frekvencije, te se obično koristi u neonatalnoj i pedijatrijskoj medicini.
Endovaginalne i endorektalne sonde
Ove sonde se koriste za specifične namjene te se postavljaju unutar šupljina, ovisno o tipu. Raspon frekvencije varira između 3,5 MhZ i 11,5 Mhz.
Sonde za Welld WED180
01.5.5743.01 R60 Konveksna sonda 3.5 MHz
01.5.5743.02 R20 Mikrokonveksna sonda 5.0 MHz
01.5.5743.03 R13/R10 Transvaginalna konveksna sonda 6.5 MHz
01.5.5743.04 HL Linearna sonda 7.5 MHz
01.5.5743.05 EL endorektalna linearna sonda 7.5MHz





Termalni papiri za videopisače
01.4.1640.00 K61 B, Made in Japan
01.4.5783.00 UPP-84 S, Made in Japan 84 mm x 12,5 m
01.4.5782.00 UPP-84 HG, Made in Japan 84 mm x 12,5 m
01.4.5369.00 UPP-110 S, Made in EU
01.4.0766.00 UPP-110 S, Made in
Kondomi namijenjeni da se navuku na ultrazvučne sonde.

01.4.3287.00 UPP-110 HD, Made in Japan
01.4.3944.00 UP-110 HG, Made in Japan
01.4.5691.00 UP-110 HG, Made in Korea 110 mm x 18 m
CTG uređaj FC 1400 / FC 1400
Šifra
01.3.5368.00
01.3.5369.00

Fetalni monitor FC1400 i fetalni monitor FC1400 Twins za praćenje blizanačke trudnoće detektiraju pokret fetusa (FM), prikazuju puls fetusa (FHR) i kontrakcije maternice (UC) u realnom vremenu na LCD zaslonu.
Tehničke karakteristike:
• Detekcija pokreta: automatska ili ručna.
• Ugrađena memorija omogućava ispis podataka i pohranu 12-satne krivulje praćenja.
• Izuzetno osjetljive ultrazvučne sonde s frekvencijom od 1MHz.
• Alarm kod odstupanja od zadanih vrijednosti pulsa fetusa (više/ niže).
• 4,7’’ LCD zaslon u boji rezolucije 320x240px.
• Ispis A4 i B5 formata na termalnom pisaču.
• Brzina ispisa: 1-2-3 cm/min
• Dimenzije: 296x305,5x97,5 mm
• Dodatne opcije: baterija, telemetrija, središnji sustav praćenja.
01.3.5368.00 - Single
01.3.5369.00 - Za blizance
Fetalni monitor 800G / 800G TWINS
Šifra
01.3.5357.00
01.3.5358.00
Detektira fetalni puls te kontrakcije maternice nakon 28 tjedana trudnoće i tako pruža referentne podatke za kliničku uporabu. Može se koristiti zasebno ili spojen s osobnim računalom preko sučelja za centralno praćenje RJ45. Prikladan za uporabu od strane stručnog medicinskog osoblja u bolnicama, klinikama, ordinacijama i u pacijentovu domu. Može stajati u vodoravnom položaju ili biti pričvršćen na zid.
Tehničke karakteristike:

• Mjerenje u normalnom rasponu fetalnih otkucaja: 120-160 otkucaja u minuti.
• LCD zaslon u boji od 8’’.
• Jasan prikaz podataka o pacijentu i krivulje praćenja.
• Ručno snimanje pokreta fetusa.
• Zvučni alarm i alarm u boji upozoravaju na visok i nizak fetalni puls.
• Funkcija kontinuiranog praćenja tijekom 24 sata u stvarnom vremenu
• Generira kontinuiranu 12-satnu krivulju praćenja te pohranjuje, prikazuje i ispisuje podatke.
• Funkcija “zamrzavanja” slike.
• Mogućnost praćenja blizanačke trudnoće.
01.3.5357.00 - 800G - SINGLE
01.3.5358.00 - 800G TWINS - ZA BLIZANCE
Fetalni monitor F6 TWIN TOCO

Pouzdan, kompaktan, lagan. 10,2” LCD zaslon u boji, 800x480px. Prikazuje brojčane podatke i valni oblik u isto vrijeme. Memorija od 12 sati. Funkcija motrenja blizanaca. Antepartum i intrapartum monitoring. US1/US2/ TOCO/FN/AMF. Ugrađen termalni pisač. Lagan za korištenje pomoću ugrađenog softvera. Odabir funkcija putem tipkovnice. Osnovne funkcije: FHR, TOCO, fetalno kretanje, automatsko raspoznavanje kanala.
Tehničke karakteristike:
• Sonda vrhunske tehnologije (9 elemenata, 2 Mhz)
• Vodootporne sonde.
• Ultrazvučni pulsni dopler s auto-korelacijom.
• Frekvencija 2 KHz;
• Frekvencija ultrazvuka 1,0 MHz ± 10%;
• Raspon FHR mjerenja 50 bpm - 240 bpm;
• Gradacija 1 bpm.
• TOCO raspon: 0 - 100 % relativno.
• Gradacija: 1 inkrement.
• Nulti način rada:
• Automatski/manualni auto-fetalni monitor;
• Doppler ultrazvučni puls AFM raspon: 0-100%.
• Gradacija: 1%.
• Kontinuirano vrijeme rada: 4 sata
• Baterija: 14,8V punjiva litij-ionska
• Signal sučelja: RS232 i Ethernet
• Brzina ispisa: 1/2/3 cm/min
• Način brzog ispisa: do 25mm/min
• Uključeni dodaci: 2 FHR sonde, 1 TOCO sonda, Event marker, 2 elastična pojasa, 1 boca gela, kabel za napajanje, 1 rola papira, RD232 kabel, CD s računalnim programom.

Učinkovit fetalni monitor, jednostavan za korištenje. Vrlo visok stupanj osjetljivosti utrazvučnog doplera, pokretanje pritiskom na jednu tipku, jednostavna instalacija. Upotreba frekvencije od 1 MHz omogućava preciznost u mjerenju. Automatska ili ručna detekcija kretanja djeteta.
Tehničke karakteristike:
• Automatski NST od 10 minuta do 1 sata.
• Ispis podataka na A4 tremalnom papiru s perforacijom.
• Brzina ispisa: 1, 2, 3 cm/min.
• Funkcija alarma (visok ili nizak puls djeteta).
• LED zaslon od 7 segmenata
• Intenzitet: <10 mW/cm2.
• Raspon vrijednosti pulsa: od 50 do 240 otkucaja u minuti (± 1 otkucaj)
• Dimenzije: 296 × 305 × 92 mm.
• Težina: cca. 2,9 kg.
Šifra
01.3.5322.00
01.3.5356.00
Edan F3 uređaj je elegantnog dizajna, sa sklopivim ekranom i poboljšanom funkcionalnošću. Veoma je lagan te je prijenosan, idealan za terensku upotrebu, ginekološke ambulante i odjele za ginekologiju/porodništvo. Edan F3 nudi ekstenzivan set parametara za mjerenje poput FHR, TOCO, DECG, IUP te fetalnog kretanja. Uz navedene pogodnosti, uređaj ima integiranu sigurnosnu memoriju za besprijekorno izvršavanje pregleda, kompatibilan je s 150/152 mm termalnim papirom te ima veliki numerički i grafički zaslon za lakšu čitljivost. Uređaj dolazi s prikladnim prostorom namijenjenim za odlaganje sonde te je veoma kompaktnog dizajna. Sklopivi crno-bijeli zaslon 5,6’’. Veliki numerički i grafički prikaz. Sigurnosna memorija omogućava kontinuirano praćenje.
Tehničke karakteristike:

Šifra
01.3.2984.00
01.3.2048.00
Dvosmjerni ručni dopler-uređaj s LCD zaslonom, prikaz valova u stvarnom vremenu, numeričkih podataka i otkucaja srca. Automatska kontrola pojačanja i adaptacija bazne linije, vrlo jednostavno rukovanje pomoću kombinacije prekidača za njihalo, tipke backspace i sonde - omogućen je jednostavan odabir načina rada i zamrzavanje vala. 30 memorijskih mjesta. USB računalno sučelje: prijenos valova i numeričkih podataka na računalo radi pohrane. Širok izbor sondi: sonde s frekvencijom od 2, 4, 5, 8 i 10 MHz. Opcionalna mala PPG sonda za napredno praćenje arterija i vena. Klinička primjena: praćenje perifernih vena, krvni tlak u donjim ekstremitetima, krvni tlak u stopalima (PPG), procjena venskog povrata(PPG), sistolički tlak u penisu, fetalni otkucaji srca (2 MHz).
Tehničke karakteristike:

• Litij-ionska baterija jamči mobilnost uređaja; stalak za sondu; mogućnost spajanja na centralni sustav za praćenje.
• Opcija: funkcije DECG i IUP.
• Dimenzije: 35 × 30 × 10,4 cm.
• Težina: 3 kg.
• Uključeni dodaci: FHR sonda;
• TOCO sonda (F2 bez DECG i IUP funkcije);
• TOCO sonda (F2 s DECG i IUP funkcijom);
• Event Marker;
• Remen;
• Gel za ultrazvuk 250 g;
• 3x Papir za ispis ((90mm×152mm×150p, US Standard, po komadu);
• 2x T2.0AH osigurač;
• Kabel za napajanje;
• odvijač;
• kabel za unutarnje povezivanje;
• punjiva litij-ionska baterija (5000mAh);
• Ethernet kabel;
• RS232 za USB adapter i Driver CD; korisnički priručnik; upute na CD-u; vodič za mjerenje fetalnog otkucaja srca.
01.3.5322.00 - Single
01.3.5356.00 - Za blizance
CTG papiri
Šifra Model Dimenzije
01.4.4129.00 Coromterics 4305 BAO 152 x 90 mm (150 listova)
01.3.5346.00 EDAN 4305 F9-G/ F2 152 x 90 mm (150 listova)
01.4.3283.00 HP M1911A 152 x 100 mm (150 listova)
01.4.2293.00 Gima 215 215 mm x 25 m
01.4.5585.00 CMS-800 G 112 x 100 mm (150 listova)
01.4.5770.00 EDAN F9-P 150 x 100 mm (150 listova)
01.4.5766.00 EDAN Cadence 112 x 90 mm (150 listova)
DRV1532 F6 TWIN TOCO 152 x 90 mm (150 listova)
• Napajanje DC 9 V (alkalne baterije vijeka trajanja oko 2,5 h).
• Automatsko isključivanje.
• Izlaz za zvučnike: 200 mW.
• Rad na nekoliko različitih frekvencija: 2, 4, 5, 8, 10 MHz; postavke načina rada: memorija (pohrana, očitanje, brisanje), smjer, skala (jedinica vremena), jezik itd.
• Zaslon: 128 × 64 piksela, STN LCD, prikaz valova, numeričkih podataka i otkucaja srca.
• Priključak za slušalice i USB.
• Dimenzije: 75 × 140 × 25 mm.
• Težina: 350 g.
01.3.2984.00 - ES-100V
01.3.2048.00 - Smart V-Link
Šifra Opis
01.3.2986.01 2 MHz
01.3.2986.02 4 MHz
01.3.2986.03 5 MHz
01.3.2986.04 8 MHz
01.3.2986.05 10 MHz


01.3.5382.00
Naš novi, sve-u-jednom kompaktni ručni doppler, SD1, izvanredan je član Edanove serije ultrazvučnih Dopplera. U usporedbi s konvencionalnim tehnologijama, SD1 donosi veliki napredak uvođenjem tehnologije pulsnog vala. Ova inovacija omogućuje korisnicima brže i jednostavnije lociranje fetalnog otkucaja srca. Izuzetno niska razina zračenja pruža sigurniji i ugodniji način korištenja uređaja. Integracija sa pametnim telefonima olakšava procjenu i pregled podataka, čineći ga prikladnijim i za kliničku uporabu i za upotrebu kod kuće, omogućujući vam korištenje uređaja bilo gdje i u bilo koje vrijeme.
Značajke:
• Sve-u-jednom dizajn
• Ugrađeni zvučnik
• Zaslon osjetljiv na dodir za jednostavno upravljanje
• Ugrađeni Bluetooth



• Pristup aplikacijama za Android ili iOS za praćenje razvoja bebe
• Sonda od 3 MHz za detekciju fetalnog otkucaja srca
• Pogonjen AA baterijama za jednostavnu zamjenu
• Tehnologija pulsnog vala
Detekcija fetalnih otkucaja sa SD1 je
• Praktičnija: Nema potrebe za postavljanjem pod posebnim kutom.
• Dublja: Poboljšana penetracija signala za pacijente različitih veličina.
• Jasnija: Znatno smanjena smetnja zvuk-šum.
Šifra Opis
01.3.2299.00 LCD ekran, sonda
01.3.0990.00 bez ekrana i bez sonde
Ultrazvučni džepni dopler namijenjen je za upotrebu u praksi zdravstvenih djelatnika uključujući medicinske sestre, primalje, tehničare za ultrazvuk i asistente liječnika, prema nalogu licenciranog liječnika u bolnicama, klinikama i privatnim ordinacijama. Uređaj ima ugrađen audiosnimač i LCD zaslon s pozadinskim osvjetljenjem. Uređaj ima automatski, prosječni i ručni način rada. Vodootporne sonde od 2 i/ili 3 MHz indicirane su za detekciju otkucaja srca fetusa od rane trudnoće pa sve do poroda, te kao opći indikator zdravlja fetusa.
Tehničke karakteristike:
• Raspon: 50-210 bpm
• Razlučivost: 1 bpm
• Vrijeme snimanja: 240s
• Audio izlaz snage: 0.5W
• Auto isključivanje: 1 minuta bez signala ili rada
• Veličina: 32 x85x138 mm
• Težina: 290 ± 5 g (uključujući bateriju)
Nova tehnologija, nova sigurnost Tradicionalni fetalni doppler koristi kontinuiranu valnu (CW) tehnologiju za detekciju otkucaja srca fetusa.
Nova tehnologija pulsnog vala (PW) značajno je povećala penetraciju signala i kvalitetu zvuka, poboljšala ukupne performanse i pružila najbolji doživljaj slušanja otkucaja srca.
SD1 predstavlja savršen spoj moderne tehnologije i praktičnosti, pružajući sigurnu, pouzdanu i udobnu opciju za praćenje fetalnih otkucaja srca.



Sonoline fetalni doppler B | C
Šifra Opis
01.3.5360.00 B
01.3.5364.00 C
Sonoline B: Tri načina prikaza: prikaz pulsa u vrijeme mjerenja, prosječna vrijednost pulsa ili ručni način. Sonda od 2 MHz. LCD zaslon. Indikator stanja baterije. Izmjenjive glave.
Sonoline C: Savitljiva glava koja olakšava pregled. Sonda od 2 MHz. LCD u boji prikazuje valni zapis zvuka te numeričke podatke. Oglašavanje alarma u slučaju nepravilnog srčanog ritma. Izmjenjive glave.



3M™ Littmann® stetoskopi pružaju visoku učinkovitost i izvanrednu akustičnu osjetljivost. Gotovo svi Littmann stetoskopi sadrže tehnologiju podesive dijafragme, izum tvrtke 3M koji omogućuje izdvajanje visokih i niskih frekvencija bez potrebe za promjenom ili okretanjem zvona.
Akustična izvedba
Idealan stetoskop za opće preglede, uključujući i mjerenje krvnog tlaka.
Lightweight II S.E.

• Dvostrano zvono
• 118 grama
• Podesiva dijafragma
• 2 godine jamstva
• Zvono: 5,4 cm
• Dvostrano zvono
Akustična izvedba


Svestran i pouzdan alat za opće fizičke preglede.


• Dvostrano zvono
• 135 grama
• 105 odnosno 95 grama
• 3 godine jamstva
• Zvono:
- Pedijatrijsko 3,3 cm / 2,5 cm
- Za novorođenčad 2,7cm / 1,9 cm
• Podesiva dijafragma
• 3 godina jamstva
• Zvono: Za odrasle - 4,3 cm
• Pedijatrijski - 3,3 cm

• Dvostrano zvono
• 150 grama
• Podesive dijafragme
s obje strane prsnog elementa
• 5 godina jamstva
• Zvono:
- Za odrasle - 4,3 cm
- Pedijatrijski - 3,3 cm
Posebne boje prsnih elemenata i slušalica dostupne su samo kod ograničenog broja boja cijevi stetoskopa.
1


Black Edition Crni zvono i crne slušalice
2


Brass Edition Zvono i slušalice boje mesinga
Iskusite tehnologiju podesive dijafragme.
LAGANI PRITISAK:
Kako biste slušali niske frekvencije, vrlo lagano prislonite glavu stetoskopa.
Akustična izvedba

4


• Jednostrano zvono
• 160 grama
• Podesiva dijafragma
• 3 godina jamstva
• Zvono: 4,4 cm 9-10 10+
Dizajniran kako bi udovoljio potrebama i najzahtjevnijih profesionalaca. Odlična akustična osjetljivost za još detaljniju dijagnozu.

• 177 grama
• Dostupno u 56 cm i 69 cm
• Dijafragma s obje strane elementa
• 2-u-1 Dvostruki lumen cijevi
• 5 godina jamstva
• Zvono: Za odrasle - 4,3cm Pedijatrijski - 3,3cm



• 185 grama
• Dostupno u 56 cm i 69 cm
• Podesiva dijafragma
• 2-u-1 Dvostruki lumen cijevi
• 7 godina jamstva
• Zvono: 5,1cm


Copper Edition Zvono i slušalice boje bakra

3 Smoke Edition Zvono i slušalice boje dima

ČVRSTI PRITISAK:
Kako biste slušali visoke frekvencije, čvrsto pritisnite glavu stetoskopa.
Akustična izvedba
Izvanredna auskultacija!

• 185 grama
• 2 godine jamstva
• Zvono: 5,1cm

• Bluetooth® wireless tehnologija
• Snimanje i reprodukcija na računalu
• 185 grama
• 2 godine jamstva
• Zvono: 5,1cm


Šifra
LITT-2450
LITT-2451
LITT-2452
LITT-2454

Zvono ovog stetoskopa dizajnirano je za jednostavnu uporabu uz manžetu za mjerenje krvnog tlaka. Svojim oblikom prati konture tijela. Podesiva dijafragma podešava se tonovima niske i visoke frekvencije bez potrebe za okretanjem zvona. Anatomske, prilagodljive slušalice s čvrstim olivama. Bez lateksa. Promjer zvona: 5,4 cm. Jamstvo 2 godine.




Šifra
LITT-2113
LITT-2119
LITT-2122
LITT-2113R

Dvostrani model sa standardnim zvonom / membranom. Veličinom i zvukom prilagođen malenim pacijentima. Plivajuća membrana. Rub koji ne hladi. Jednostruki lumen cijevi. Promjer zvona: za bebe 2,5 cm i za djecu 3,3 cm.






LITTMANN Classic II - za novorođenčad
Šifra
LITT-2114
LITT-2124
LITT-2114R
LITT-2157

Poseban dizajn i prilagođena veličina za pregled najmanjih pacijenata. Zvono promjera za bebe: 2,7 cm i nedonoščad 1,9 cm. Dvostrani model s plivajućom membranom omogućuje slušanje na niskoj i visokoj frekvenciji. Rub koji ne hladi. Bez lateksa. Anatomske slušalice.







Šifra
LITT-5627
LITT-5839
LITT-5623
LITT-5835
LITT-5622

Šifra
LITT-5620
LITT-5621
LITT-5831
LITT-5832
LITT-5633



Visoka akustična osjetljivost i iznimne performanse kada se rade opće fizičke procjene. Podesiva dijafragma. Dvostrano zvono moderniziranog dizajna koji je sada lakše čistiti i održavati. Nova generacija materijala za izradu crijeva otpornija na ulja i alkohol. Promjer zvona za odrasle 4,3 cm, a za djecu 3,3 cm. Pet godina jamstva.

Šifra
LITT-5803
LITT-5811
LITT-5806
LITT-5807
LITT-5809







Šifra
LITT-6156
LITT-6152
LITT-6155
LITT-6154
LITT-6158

Visoka akustična osjetljivost i iznimne performanse kada se rade opće fizičke procjene. Podesiva dijafragma. Dvostrano zvono moderniziranog dizajna koji je sada lakše čistiti i održavati. Nova generacija materijala za izradu crijeva otpornija na ulja i alkohol. Promjer zvona za odrasle 4,3 cm, a za djecu 3,3 cm. Pet godina jamstva. Posebna kombinacija boja.





Unaprijeđen dizajn i poboljšana razlučivost visokih frekvencija. Dvostruki lumen cijevi. Jednodijelna podesiva membrana omogućava slušanje visokih i niskih frekvencija na obje strane (za odrasle i djecu) zvona. Promjer zvona: za odrasle 4,3 cm i za djecu 3,3 cm. Pedijatrijska strana zvona se može pretvoriti u otvoreno zvono.





LITTMANN
Šifra
LITT-6163
LITT-6168
LITT-6165
LITT-6179
LITT-6177
LITT-6170

Zvono završne obrade: dim, crno, duga, mesing, šampanjac, ogledalo.








Šifra
LITT-2160
LITT-2163
LITT-2164
LITT-2167
LITT-2161
LITT-2175
LITT-2176


Pogodan za: kardiologiju, pulmologiju, anesteziju i internu. Ručno izrađeno čvrsto zvono. Dvostruki lumen cijevi. Posebni adapteri za mjesta otežanog pristupa i pedijatrijsku auskultaciju. Membrana koja ne hladi pacijente. Jednostruko Master zvono s podesivom membranom koje pritiskom razdvaja visoke od niskih frekvencija.






Šifra Opis
LITT-36573-1set
LITT-40002
LITT-40006
LITT-40012
LITT-40013
LITT-40016
LITT-40017
LITT-40018
LITT-40021
LITT-40023
Okvir i membrana za pedijatrijsku stranu stetoskopa Littmann Cardiology III,siva boja
Komplet rezervnih sivih, mekih oliva za Littmann stetoskope, 1 par malih, 1 par velikih
Komplet rezervnih dijelova za Littmann Classic II; membrana s okvirom i rubnik koji ne hladi, par oliva, sivo
Komplet rezervnih dijelova za Littmann Classic II pedijatrijski; membrana sa sivim i crnim okvirom
Komplet rezervnih dijelova za Littmann Classic II infant; membrana sa sivim i crnim okvirom
Komplet rezervnih dijelova za Littman Classic III; membrane za odraslu i pedijatrijsku stranu, par oliva, crno
Komplet rezervnih dijelova za Littmann Classic III; membrane za odraslu i pedijatrijsku stranu, par oliva, sivo
Komplet rezervnih dijelova za Littmann Master Cardiology; okvir i membrana, par oliva, sivo
Komplet rezervnih dijelova za Littmann Lightweight II; membrana s okvirom i rubnik koji ne hladi, par oliva, smeđe
Komplet rezervnih dijelova za Littmann Master Classic II; okvir i membrana, par oliva, sivo
Stetoskop Littmann Core digital električni crni, 69 cm
Šifra LITT-8490

Digitalni stetoskop 3M™ Littmann® CORE ima izvanrednu akustiku, udobnost i kvalitetu Littmann srčanih stetoskopa, dodatno poboljšane snažnom digitalnom tehnologijom. Značajke kao što su pojačanje od 40x i aktivno smanjenje šuma mogu vam pomoći da slušate s više samopouzdanja. Stetoskop 3M Littmann CORE povezuje se s Eco sof tverom na vašem pametnom uređaju (uključujući vaš mobilni telefon) za vizu alizaciju, snimanje i dijeljenje podataka. Stetoskop 3M Littmann CORE kompa tibilan je s iOS i Android uređajima s Eco softverom, što vam omogućuje sprema nje i označavanje snimaka od 15, 30, 60 ili čak 120 sekundi putem sigurne nad zorne ploče - sve u skladu sa zahtjevi ma HIPAA. 3M Littmann CORE digitalni stetoskop je unaprijed sastavljena kom binacija CORE digitalnog nastavka i 3M Littmann Cardiology IV stetoskopa. Pojačanje od 40x temelji se na razlici između analognog i elektronički pojačanog slušanja pri maksimalnoj izlaznoj glasnoći na vršnoj frekvenciji (125 Hz). Pametni uređaj nije uključen. Mekane slušalice pružaju izvrsno akustično zatvaranje i udobno prianjanje. Podesive, dvostrane slušalice od nehrđajućeg čelika s otvorenim ili zatvorenim zvonom. Rješenje “Dvije cijevi u jednom” s dvostrukim lumenima. Boja cijevi Crna. Opremljen dodatnim čepićima za uši. Težina slušalica: 87g. Vrsta slušalica: Duplex. Vrsta čepića za uši: mekana maslinasta. Membrana malog promjera (jedinica) 3,3 cm. Promjer membrane 4,3 cm. Vrsta membrane: Podesiva. Neto težina (metrička) 232 g. Duljina: 69 cm. Boja proizvoda Crna. Jamstveni rok 2 godine.


Stetoskop Riester Cardiophon 2.0
Šifra
01.8.5426.01
Poboljšana akustika, osobito u frekvencijskom rasponu između 200 i 500 Hz. Dvostruki prsni dio izrađen od nehrđajućeg čelika, dvostrana specijalna membrana za preciznu akustiku; Ø 44 mm i 32 mm; s rubom koji ne hladi. Duljina: 71 cm, težina: 204 g, bez lateksa. Dodaci: dva para zamjenskih oliva, dvije zamjenske membrane i pločica za ime.

Stetoskop Riester Tristar® s membranama Duplex®, Duplex® Baby i Duplex® Neonatal
Šifra
01.8.1117.01
01.8.1117.02

Stetoskop visoke kvalitete s trima dvostrukim aluminijskim zvonima različite veličine (za odrasle, djecu i novorođenčad) prikladan je za auskultaciju u svim rasponima frekvencije. Posebne membrane Ø 48, 36 i 28 mm. Plosnati rubovi koji ne hlade omogućavaju bolju adaptaciju koži pacijenta. Ukupna duljina: 79 cm, 78,5 cm, 78 cm. Izrada bez lateksa. Dodaci: zamjenske olive, tri zamjenske membrane i pločica za ime.
01.8.1117.01 (RI4093) | siva
01.8.1117.02 (RI4091) | plava

Stetoskop Riester duplex®
Šifra
01.8.1427.01
01.8.1427.02
01.8.1427.03

Stetoskop visoke kvalitete s dvostrukim zvonom. Materijal: lagani, galvanizirani aluminij. Specijalna membrana - Ø 48 mm - omogućuje savršenu auskultaciju; osobito plosnat i mekan rub koji ne hladi prilagođava se koži pacijenta. Zvono: Ø 36 mm. Ukupna duljina: 77 cm. Dodaci: par zamjenskih oliva i zamjenska membrana. Pogodan za pregled odraslih i djece.
01.8.1427.01 | RI4001-01 - plava
01.8.1427.02 | RI4001-02 - siva
01.8.1427.03 | RI4001-03 - crna

Stetoskop KaWe Planet prema Fassbenderu
Šifra
01.8.3156.00
Dvostrana, fleksibilna i prilagodljiva glava. Membrana: Ø 44 mm. Izvanredne akustične performanse. Duljina oko 75 cm. Crna boja.

Stetoskop KaWe Prestige Standard, za odrasle
Šifra
01.8.0459.01
01.8.0459.02
01.8.0459.03
Membrana: Ø 44 mm. Mekane olive. Zamjenske olive. Glava izrađena od nehrđajućeg čelika.
01.8.0459.01 | crna
01.8.0459.02 | bordo
01.8.0459.03 | plava

Stetoskop KaWe Prestige za djecu i novorođenčad
Šifra
01.8.1387.01
01.8.2086.01
01.8.2086.02
Membrana: Ø 35 mm za djecu, Ø 28.5 mm za novorođenčad. Duljina: otprilike 78 cm s glavom od nehrđajućeg čelika. Mekane olive (plus rezervne olive).
ZA DJECU:
01.8.1387.01 - crvena
ZA NOVOROĐENČAD:
01.8.2086.01 - bordo
01.8.2086.02 - crna


Stetoskop KaWe RappAPort
Šifra
01.8.0060.01
01.8.0060.02
01.8.0060.03
01.8.0060.04
01.8.0060.05

Stetoskop s dvostrukim zvonom i vrhunskim akustičkim performansama.Prikladan za pregled odraslih i pedijatrijskih pacijenata, membrana: Ø 40 mm. Duljina cijevi: cca 55 cm. Veliki komplet zamjenskih dijelova. Izrada bez lateksa.
01.8.0060.01 | lila
01.8.0060.02 | zelena
01.8.0060.03 | plava
01.8.0060.04 | crna
01.8.0060.05 | crvena

Stetoskop KaWe Colorscop Duo
Šifra
01.8.0348.01
01.8.0348.02
01.8.0348.03
01.8.0348.04
01.8.0348.01 | crvena
01.8.0348.02 | crna
01.8.0348.03 | plava
01.8.0348.04 | zelena
01.8.0348.05 | žuta
01.8.0348.06 | lila
01.8.0348.07 | tirkizna
01.8.0348.08 | pink
Šifra
01.8.0348.05
01.8.0348.06
01.8.0348.07
01.8.0348.08

Stetoskop KaWe Colorscop Plano
Šifra
01.8.5413.01
01.8.5413.02
01.8.5413.03
01.8.5413.04
01.8.5413.01 | crvena
01.8.5413.02 | crna
01.8.5413.03 | plava
01.8.5413.04 | zelena
01.8.5413.05 | žuta
01.8.5413.06 | lila
01.8.5413.07 | tirkizna
01.8.5413.08 | pink
Šifra
01.8.5413.05
01.8.5413.06
01.8.5413.07
01.8.5413.08

Par oliva za KaWe Duo i Plano stetoskope
Šifra
01.8.0670.00

Profesionalni kardiološki stetoskop Rossmax EB-600
Šifra
Poput Littmann modela. Akustički superosjetljiv. Napredna konstrukcija od nehrđajućeg čelika; dva izmjenjiva zvona; mekane slušalice. Uključena dodatna dijafragma. Bez lateksa.

Stetoskop Rex-Scope
01.8.5418.01
01.8.5418.03
Pouzdan stetoskop s vrhunskim akustičnim performansama. Za odrasle i djecu. Mekane olive.
01.8.5418.01 | bordo
01.8.5418.03 | plava

Stetoskop KaWe Pinard
Šifra
Stetoskop za mjerenje tlaka Rossmax EB-100
Šifra
Mekane slušalice. Glava stetoskopa koja ne hladi. Posebno dobro prilagođen za rad s tlakomjerima.

KaWe stetoskop za praktičnu nastavu za medicinske sestre
Šifra
01.8.0453.00
Dva para slušalica. Y-cijev: 110 mm. Membrana: Ø 43 mm.

Duljina: cca 17 cm. Ø 44 mm. Izrađen od bukovine . Idealan za primalje i buduće roditelje

Klasična futrola za stetoskop
01.8.0068.00 Šifra
GIMA-32667
GIMA-32668
GIMA-32669
Visokokvalitetna zaštitna tvrda futrola za klasične stetoskope, dostupna u 3 boje. Dizajn futrole drži stetoskop sigurno na mjestu zahvaljujući prethodno oblikovanoj unutrašnjosti, štiteći osjetljivu dijafragmu i cijev. Unutarnji mrežasti džep za dodatno spremanje pribora. Vanjske dimenzije: 28x16x5 cm; unutarnje dimenzije: 26,5x14,5x4 cm. Težina: 220 g.
GIMA-32667 | crna
GIMA-32668 | bordo
GIMA-32669 | plava


Navlaka za stetoskop
Šifra
01.8.5430.06
Pristaje na svaki stetoskop. Zabavlja male pacijente.

Navlaka za stetoskop
Šifra
GIMA-32653
GIMA-32654
Navlaka za stetoskope u obliku svinje, za pedijatrijsku primjenu, odgovara svim vrstama stetoskopa.
GIMA-32653 | - svinja
GIMA-32653 | - krokodil


Šifra
01.9.0495.00
01.9.2037.00
01.9.5377.00
KaWe EUROLIGHT® F.O. otoskopi

Vam osiguravaju optimalne uvjete za jednostavan ENT tretman kroz kvalitetnu svjetlosnu tehnologiju, s uvećanjem do 2,5 puta i robusnom metalnom drškom. Serija Eurolight modela dolazi u tri različite varijante - C, FO i Eurolight C30 FO LED Standard. Svi modeli imaju opciju podešavanje svjetla pomoću reostata, te dolaze s 20 spekuluma (promjera 2,5 i 4,0mm) i torbicom na čičak. Uređaj koristi 2 AA baterije (nisu uključene u cijenu).
Eurolight C - Klasični model s vakuumskom žaruljom, snage 2.5V.
Eurolight FO - Model s optičkim vlaknima i 2.5V vakuumskom žaruljom
Eurolight FO LED Standard - LED žarulja svjetline 8.000 lux, radnog vijeka cca 100.000 sati
01.9.0495.00 | Eurolight C
01.9.2037.00 | Eurolight FO
01.9.5377.00 | Eurolight C30 FO LED Standard
01.9.5377.00 Vakuum Standardno Na vijak
01.9.2037.00 Vakuum Standardno Na vijak
01.9.0495.00 LED 8.000 lux Bez vijka
Šifra
01.9.5671.01
01.9.5671.02
01.9.0146.01
01.9.0146.02
01.9.5378.01
01.9.5378.02
eScope otoskopi koriste vrhunsku tehnologiju umanjenja refleksije svjetla pomoću koje se pospješuje preciznost dijagnoze te smanjuju troškovi održavanja. Trostruko uvećanje - Minimalni odraz zbog asferičnih leća. Ravnomjerna raspodjela svjetla preko površine | Jednostavna zamjena žarulje. Kućište od ABS plastike otporno na udarce U ponudi imamo tri različita modela Riester stetoskopa:
e-Scope - Klasični model s ksenonskom žaruljom jačine 2,5 V.
e-Scope FO s optičkim vlaknima za fokusiranje i namještanje svjetlosnog snopa.
e-Scope FO LED serija s optićkim vlaknima te LED žaruljom daje iznimno jako svjetlo.
Šifra
01.9.5672.01
01.9.5672.02
01.9.5672.03
01.9.5674.01
01.9.5674.02
01.9.5674.03

KaWe PICCOLIGHT® F.O. otoskopi Vam osiguravaju optimalne uvjete za jednostavan ENT tretman kroz kvalitetnu svjetlosnu tehnologiju, s uvećanjem do tri puta i robusnom drškom. Serija Piccolight modela dolazi u četiri različite varijante - C, FO, FO LED Standard i FO. Svi modeli dolaze s 20 spekuluma (promjera 2,5 i 4,0mm) te torbicom na čičak. Uređaj kjoristi 2 AA baterije (nisu uključene u cijenu).
Piccolight C - Klasični model s vakuumskom žaruljom, snage 2.5V.
Piccolight FO LED Standard - LED žarulja svjetline 8.000 lux, radnog vijeka cca 50.000 sati
01.9.5672.01 | Piccolight C | crna
01.9.5672.02 | Piccolight C | plava
01.9.5672.03 | Piccolight C | srebrna
01.9.5674.01 | Piccolight FO LED Standard | crna
01.9.5674.02 | Piccolight FO LED Standard | plava
01.9.5674.03 | Piccolight FO LED Standard | srebrna
Šifra Žarulja Osvjetljenje Dostupne boje
01.9.5672 Vakuum Standardno Crna, plava, bijela
01.9.5674 LED Standardno Crna, plava, bijela




01.9.5671.01 | e-Scope | bijela
01.9.5671.02 | e-Scope | crna
01.9.0146.01 | e-Scope


Otoskop Heine Mini 3000
Šifra
D-001.70.120
D-008.70.110
D-008.70.120_

Moderni otoskop jedinstvenog kompaktnog dizajna s izravnim osvjetljenjem, namijenjen za korištenje isključivo s originalnim HEINE Mini drškama. Svi otoskopi imaju zajamčenih 20 000 uključenja i isključenja. Jednostavan za korištenje, dostupan u tri glavne varijante:




Poboljšana XHL ksenonska halogenska tehnologija pruža 100% više svjetla u odnosu na konvencionalne žarulje bijelim koncentriranim svjetlom. Heine Mini 3000 XHL
Tehničke karakteristike:
• Ugrađeni pomični prozorčić s 3x uvećanjem
• Drška otporna na udarce izrađena od kroma i visokokvalitetne plastike
• Klipsa s integriranim prekidačem
• Radi na zamjenjive AA baterije ili baterije punjive s Mini NT uređajem
• Dodaci: 10 jednokratnih lijevaka (5x 2,5 mm i 5x 4mm)


Heine Mini 3000 XHL FO
Ksenoska halogena žarulja intenzivnog osvjetljenja i točnog prikaza boje na principu optičkih vlakana bez odraza.
Tehničke karakteristike:
• Ugrađeni pomični prozorčić s 3x uvećanjem
• Pneumatsko testiranje bubnjića s nastavkom za insulaciju
• Klipsa s integriranim prekidačem
• Radi na zamjenjive AA baterije ili baterije punjive s Mini NT uređajem
• Nagrađivani dizajn
• Dodaci: 10 jednokratnih lijevaka (5x 2,5 mm i 5x 4mm) + 4 višekratna lijevka
Heine Mini 3000 LED FO
Otoskop s briljantnim LED osvjetljenjem, homogeno osvjetljenje visokog intenziteta, boje 4000K, dvaput jačeg intenziteta u odnosu na ksenon-halogene žaruljhe.
Tehničke karakteristike:
• Indikator napunjenosti baterije koji prilagođava svjetlo ovisno bateriji
• Omogućeno do 10 sati neprekidnog rada
• Intenzitet svjetla cca 8500 luksa
• Vijek trajanja žarulje: 50 000 sati
• Trostruko uvećanje
• Dodaci (A): 10 jednokratnih lijevaka (5x 2,5 mm i 5x 4mm)
• Dodaci (B): 10 jednokratnih lijevaka (5x 2,5 mm i 5x 4mm) + 4 višekratna lijevka
D-008.70.110
Pruža uvećanje od 2.5x, može se koristiti kao dijagnostička svjetiljka ili kao otoskop. Integrirana staklena žaruljica omogućava dobro osvjetljenje slušnog kanala. Sadržaj: nastavak - mini otoskop, dijagnostička svjetiljka, lijevci za višekratnu upotrebu Ø4.5 mm. Pakirano u kutiji. Baterije AAA ne dolaze u pakiranju.

Kompaktan i siguran profesionalni otoskop namijenjen za pregled bubnjića i vanjskog uha. Rezolucija od 1.3 megapiksela i uvećanje od 55-90X. Dolazi s izmjenjivim ušnim lijevcima promjera 3, 4 i 5 mm (po 10 komada svaki). 6 LED žaruljica paljenje/gašenje na prekidač. Bijelo svijetlo. Maksimalni broj prikaza sličica u sekundi: 30 fps. USB 2.0 priključak. Medicinski uređaj klase 1. Dimenzije: 10,5 cm (L) x 3,2 cm (D). Težina: 95 g.


RE-VO2 novi, lagan i prijenosan digitalni video otoskop vrhunske kvalitete iz Resonancea
RE-VO2 omogućuje detaljan pregled uha s izuzetnom preciznošću, pružajući visokokvalitetne slike ili videozapise s prirodnom i preciznom reprodukcijom boja za točnu dijagnostičku procjenu. Lagan i prijenosni uređaj s optikom posebnog dizajna, LED rasvjetom visokog intenziteta, visokorezolucijskim senzorom slike i izvrsnom kamerom, uređaj namijenjen sigurnoj dijagnostici.



Ušni lijevci za KaWe EUROLIGHT® C
Šifra
01.9.2776.01
01.9.2776.02
100 kom u pakovanju. Cijena po komadu.
ZA JEDNOKRATNU UPOTREBU
01.9.2776.01 | Ø 2,5 mm
01.9.2776.02 | Ø 4 mm
ZA VIŠEKRATNU UPOTREBU
Šifra
01.9.0649.00


3 komada: Ø 2,5/3,5/4,5 mm. Moguće sterilizirati u autoklavu do 134° C.
Ušni lijevci za KaWe PICCOLIGHT® i EUROLIGHT® FO, za jednokratnu upotrebu
Šifra
01.9.1506.01
01.9.1506.02
100 kom u pakovanju. Cijena po komadu.
01.9.1506.01 | Ø 2,5 mm
01.9.1506.02 | Ø 4 mm

Ušni lijevci za KaWe EUROLIGHT C® (veterinarski otoskop) za višekratnu upotrebu
Šifra
01.9.1371.00

3 komada: Ø 4,0/5,0/7,0 mm. Moguće sterilizirati u autoklavu do 134° C.
Performanse:
• Senzor slike: Visokokvalitetni senzor boje, 1/9”
• Veličina piksela: 1.4μm x 1.4μm
• Spekulumi: Heine 4 mm
• Rezolucija: 1280 (h) x 720 (v)
• Automatske prilagodbe: AGC, AES, AWB
• Dinamički raspon: 68.4 dB
• Omjer signal/šum: 36.4 dB ili više
• Kut gledanja leće (vidno polje): (D) 88° +/- 5°
• Dubina polja: 10 mm – 30 mm
• Izvor svjetlosti: Bijeli LED visokog intenziteta
• Ulaz napajanja: DC – 5V putem USB tipa C
• Sustav izlaza: Preko USB tipa C, bez dodatnog upravljačkog programa
• Potrošnja energije: 1W
• Težina/Dužina/Dužina kabela: 100g/16.8 cm/2 m
• Povezivost: Spajanje s računalom putem USB tipa C za snimanje, pregled i pohranu slika
• Kompatibilnost: Windows 11
Riester višekratni lijevci za E-Scope® otoskope
Šifra
01.9.5698.01
01.9.5698.02
10 kom/pak. Za odrasle i djecu.
01.9.5698.01 (RI10779) | Ø 2,5mm
01.9.5698.02 (RI10789) | Ø 4mm

Ušni lijevci - za Riester otoskope
Šifra
B-000.11.128_
B-000.11.127_

Jednokratni lijevci za Heine otoskope (BETA400, BETA200, K180, mini 3000 F.O., mini 3000 otoskopi). Pakiranje od 1.000 komada. Promjer 4 mm. Za odrasle. Siva boja.
B-000.11.128_ (RI10779) | Ø 2,5mm
B-000.11.127_ (RI10789) | Ø 4mm
Šifra
B-000.11.111 Šifra

Set višekratnih Sanalon lijevak a za Heine otoskope, 4 lijevka u setu - 2,4 mm, 3,0 mm, 4,0 mm, 5,0 mm. Set (4 kom.)
Jednokratni lijevak za video otoskop MS 101 ELITE. 250 komada u pakiranju. Veličina: Promjera 5 mm. Boja: Crna.
KaWe MedCharge® 4000
Šifra
LED-žaruljica za KaWe F.O. otoskope
Puni baterije laringoskopa, otoskopa i dermatoskopa. Dva adaptera za drške. Može se montirati na zid. Za KaWe baterije od 2,5 i 3,5 V (NiMH, NiCd i Liion). Napajanje: 230 V.

Komplet Mini NT® - stolni punjač baterija
07.2.3398.00 Šifra
01.9.5000.00 Šifra
Namijenjen za uređaje iz serije mini 3000. Uključuje: punjač, 2 punjive baterije, 2 zatvarača za punjenje. Prikladan samo za punjenje baterija tipa NiMH od 2,5 V. Vrijeme punjenja: 4 sata. 5 godina jamstvo!

01.9.2703.00
Eurolight E10 oftalmoskop pruža postojano i ravnomjerno osvjetljenje i daje široko pregledno polje očne pozadine. Sklapa se na vijak. Jedna apertura. Vakuumska žaruljica. Podešavanje intenziteta svjetla pomoću reostata. Metalna baterijska drška / drška za punjenje C. Korekcija dioptrije: +20 do -20.


01.9.3393.00
Optimalno osvjetljenje očne pozadine. Šest apertura: crtica, veliki krug, mali krug, polukrug, veliki zeleni krug, križić. Sklapanje na klik, metalna baterijska drška - EU inačica. Podešavanje intenziteta svjetla pomoću reostata. Halogena žaruljica od 2,5 V. Asferična optika. Korekcija dioptrije: +/- 20 dioptrija. Napajanje: 2 baterije tipa “C” (nisu uključene). Dodaci: torbica.

07.2.0142.00

Trajanje baterije 80h. Osvjetljenje 70.000 luksa. Temp. boje: 5500 K. Vijek trajanja: 100.000h .
Žarulja za Kawe otoskop, FO LED standard
01.9.5686.00
FO LED standard.

Žaruljica za otoskop Mini 3000 f.o. 2.5V
01.9.4437.00

Visoka optička kvaliteta. Jak i uniformirani intezitet svjetla. Trajnost. Pouzdana zaštita od implozije žaruljice.
01.9.0680.01
01.9.0680.02
01.9.0680.03
Moderan dizajn. Veliko pregledno polje. Konvencionalna vakuumska žaruljica od 2,5 V pruža optimalno osvjetljenje i trostruko uvećanje. Korekcija dioptrije +/- 20 dioptrija i jedna dijafragma: veliki krug. Plastična drška za baterije (2× “AA”, 1,5 V, nisu uključene).

01.9.3394.01
01.9.3394.02
01.9.3394.03
Precizno osvjetljenje očne pozadine bez stvaranja sjena, halogena žarulja od 2,5 V. Korekcija dioptrije: +/-20 dioptrija i 6 dijafragmi, asferična optika. Šest apertura: crtica, veliki krug, mali krug, polukrug, veliki zeleni krug, križić). 2 x“AA”(nisu uključene) ili KaWe-ova punjiva baterija.

RIESTER Uni® II May oftalmoskop s 2.7V C-drškom
Šifra

Serija UNI pruža liječnicima i studentima medicine jednostavan i cijenom povoljan dijagnostički set čvrstog dizajna. Nudi upravo ono što je potrebno kako bi se zadovoljili svi uvjeti rada. Oftalmoskop UNI II May ima standardno osvjetljenje od 2,7 volta, kromiranu baterijsku ručku tipa ‘C’, a intenzitet svjetla podesiv je s pomoću reostata.
Oftalmoskop Riester RI-scope L3
01.9.5682.00
Oftalmoskop HEINE Mini 3000® LED na nepunjive baterije
01.9.5681.00 Šifra

Dodatna funkcija za fokusiranje s nultom silom zadržavanja za brzu korekciju ametropija. 89 dioptrijskih vrijednosti (+1-45 u pojedinačnim koracima; -1-44 u pojedinačnim koracima). Jednostavno rukovanje aperturama (polukrug, mali/ srednji/veliki krug, fiksacijska zvjezdica, prorez i mreža). Filter za sve aperture uzprikaz simbola, filter koji ne propušta crvenu boju, plavi filter i polarizacijski filter. Zaštita od prašine. Napajanje: 2 litijske baterije.
01.9.5693.00

Moderan oftalmoskop s dodatnim prednostima: nije potrebno održavanje ni zamjena LED žarulje zbog dugog vijeka trajanja; svjetlina i prikaz boja mogu se usporediti s oftalmoskopom HEINE XHL Xenon Halogen. Homogeno osvjetljenje visokog intenziteta omogućava vrlo precizan prikaz boje: temperatura boje 4000 K, indeks uzvrata boje > 95; indeks uzvrata crvene boje > 90. Ekskluzivni indikator napunjenosti baterije: pri uključenju svjetlo će biti najvišeg intenziteta, a zatim će se smanjiti na razinu koja odgovara trenutnom stanju napunjenosti baterije. Do 10 sati neprekidnog rada. Izrada: kombinacija kroma i plastike visoke kvalitete i otpornosti.
Oftalmoskop Riester E-Scope®
01.9.5379.00
Serija UNI pruža liječnicima i studentima medicine jednostavan i cijenom povoljan dijagnostički set čvrstog dizajna. Nudi upravo ono što je potrebno kako bi se zadovoljili svi uvjeti rada. Oftalmoskop UNI II May ima standardno osvjetljenje od 2,7 volta, kromiranu baterijsku ručku tipa ‘C’, a intenzitet svjetla podesiv je s pomoću reostata.

Glava za oftalmoskop HEINE BETA® 200 Drška i žaruljica XHL za oftalmoskop
01.9.1815.00

Oftalmoskop sa svim karakteristikama oftalmoskopa HEINE BETA 200S (jedna apertura manje). Jedinstvena asferična optika. Eliminiran odraz rožnice i šarenice. Tehnologija XHL Xenon Halogen (2,5 V) proizvodi intenzivno bijelo svjetlo. Šest apertura i 27 leća s korekcijom dioptrije od -35 do + 40.
Glava za oftalmoskop HEINE BETA® 200S

Superiorna asferična optika (odvojene zrake za osvjetljenje i pregled) i 74 dioptrije. Eliminiran odraz rožnice i šarenice. Tehnologija XHL Xenon Halogen (2,5 V) proizvodi intenzivno bijelo svjetlo. Raspon leća: -36 D do +38 D - savršen fokus čak i kod velikih refrakcijskih grešaka. Sedam apertura s odvojenim filterom koji ne propušta crvenu boju - prikladne su za velike i male zjenice: prorez, fiksacijska zvjezdica, kobaltno plavi filter i filter koji ne propušta crvenu boju. Višestruko obložen prozorčić za promatranje. Zaštita od prašine. Precizno, trajno metalno postolje ergonomski oblikovano.
BETA® 200 Heine


Visoka kvaliteta, jaka i izdržljiva metalna konstrukcija. Automatsko, brzo i sigurno sklapanje. Svjetlina podesiva pomoću reostata. Površina ručke obrađena na način da ne klizi iz ruke. Zaštita od kratkog spoja. Kontinuirana kontrola kvalitete osvjetljenja. Dimenzije: 145 × 30 mm. Napajanje: baterija od 2,5 V (nije uključena).
01.9.3738.00 | Drška za oftalmoskop BETA® 200 Heine X-01.88.069 | Žaruljica XHL za oftalmoskop BETA® 200 Heine

Dijagnostički komplet otoskop /oftalmoskop
KaWe EUROLIGHT® C10/E10
Šifra
01.9.2783.00
Glava za otoskop KaWe EUROLIGHT® C10, 2,5 V; standardno osvjetljenje ; trostruko uvećanje; vakuumska žaruljica. Glava za oftalmoskop EUROLIGHT® E10 , 2,5 V; korekcija dioptrije od +20 do -20; 1 dijafragma; vaku. žaruljica. Drška s baterijom koja je punjiva u postaji za punjenje KaWe MedCharge ® 4000; sklapanje na vijak; mogućnost podešavanja intenziteta svjetla. Baterije: 2 C baterije; 1,5 V (nisu uključene). Ušni lijevci za jednokratnu upotrebu: 10 × Ø 2,5 mm, 10 x Ø 4,0 mm. Pakiranje: crna plastična kutija.

Dijagnostički komplet otoskop/oftalmoskop | KaWe PICCOLIGHT FO/E56 - šest apertura
Šifra
01.9.5750.00
2,5 V - otoskopska glava: KaWe PICCOLIGHT F.O. LED; LED žarulja s trostrukim povećanjem; priključak za pneumatsko ispitivanje. 2,5 V - oftalmoskopska glava: KaWe PICCOLIGHT E56; xenonska / halogena žarulja; 6 otvora; s kotačićem za korekciju leće u inkrementalnim koracima od +20 do –20 dioptrija; asferična precizna optika. 2,5 V - 2 ručke: baterije: 2x Mignon AA (baterije nisu uključene). Ušni lijevci: 10 x Ø 2,5 mm, 10 x Ø 4 mm.

Dijagnostički komplet otoskop/oftalmoskop
Kawe Basic
Šifra
01.9.2932.00
Metalna drška EUROLIGHT®.
Glava oftalmoskopa E10 (1 dijafragma, korekcija dioptrije +/- 20 dioptrija, postojano i ravnomjerno osvjetljenje). Glava otoskopa: standardno osvjetljenje, 2,5 V; trostruko uvećanje; 3 višekratna ušna lijevka Ø 2,5/3,5/4,5 mm; zamjenska žaruljica. Kromirani nosni spekulum. Čvrsta kutija. Baterije nisu uključene.

Dijagnostički komplet otoskop/oftalmoskop
KaWe COMBILIGHT® FO 30 / E30
Šifra
01.9.3508.00

Glava za otoskop COMBILIGHT® C10, 2,5 V; rad na principu optičkih vlakana; trostruko uvećanje; ksenonska žaruljica. Glava za oftalmoskop EUROLIGHT® E30 , 2,5 V; korekcija dioptrije od +20 do -20; 1 dijafragma; vakuumska žaruljica. Drška s baterijom koja je punjiva u postaji za punjenje KaWe MedCharge® 4000; sklapanje na vijak; mogućnost podešavanja intenziteta svjetla. Baterije: 2 C baterije; 1,5 V (nisu uključene). Ušni lijevci za jednokratnu upotrebu: 10 × Ø 2,5 mm, 10 x Ø 4,0 mm. Pakiranje: crna plastična kutija.
Dijagnostički komplet otoskop/oftalmoskop
KaWe PICCOLIGHT® F.O. - jedna apertura
Šifra
01.9.2842.03
Glava otoskopa: rad na principu optičkih vlakana; halogena žaruljica; trostruko uvećanje. Glava oftalmoskopa E50 s korekcijom dioptrije +20 do -20; vakuumska žaruljica. Napajanje: 2 baterije tipa “AA”. Torbica. Ušni lijevci: 10 kom Ø 2,5 mm, 10 kom Ø 4,0 mm.

Dijagnostički komplet otoskop/oftalmoskop
KaWe PICCOLIGHT® C - jedna apertura
Šifra
01.9.2784.01
01.9.2784.02
01.9.2784.03
Glava otoskopa: standardna vakuumska žaruljica; 3x uvećanje. Glava oftalmoskopa E50 s korekcijom dioptrije +20 do -20. Vakuumska žaruljica. Baterijska drška.
01.9.2784.01 | crna 01.9.2784.02 | plava 01.9.2784.03 | siva

KaWe MedCenter® 5000 C i 5000 F.O. LED
Šifra
01.9.5380.00
01.9.5381.00
Zidni dijagnostički set. Automatsko paljenje kod uzimanja u ruku. 24-satni standby. Prilagođavanje svjetline na prekidač. Ergonomske drške. Jednostavno montiranje na zid. Izlazna snaga: 3.5V. Napajanje: 100-230 V, 50/60 Hz. Izlazna struja: 200 mA.

01.9.5380.00 - MedCenter 5000 C sadrži: otoskop C i oftalmoskop E55 (ksenonska žarulja).
01.9.5381.00 - MedCenter 5000 F.O. LED sadrži: otoskop F.O. LED i oftalmoskop E56 (high power LED).
Heine Mini 3000 F.O. dijagnostički set
Šifra D-886.11.021
Multifunkcionalna kamera s Ri-screen drškom sa zaslonom i punjivom litij ionskom baterijom
Šifra
01.9.5701.00
01.9.5702.00
01.9.5703.00
01.9.5700.00

Ri-screen je kompletan sustav s digitalnom medicinskom kamerom za cijeli niz oftalmoskopskih, otoskopskih, dermatoskopskih i ostalih primjena. Uključena je kamera, držač, zaslon, utor za USB i AV. Glave se kupuju zasebno.
01.9.5701.00 | Otoskop (glava)
01.9.5702.00 | Oftalmoskop (glava, leća 25°)
01.9.5703.00 | Dermatoskop (glava)
01.9.5700.00 | Multifunkcionalna kamera
Komplet sadrži: mini 3000 oftalmoskop s baterijskom drškom, mini 3000 F.O. otoskop s baterijskom drškom, 1 set (4 kom.) višekratnih lijevaka (B-000.11.111) 5 jednokratnih lijevaka promjera 2.5mm i 5 jednokratnih lijevaka promjera 4 mm i čvrsti kofer.


Dermatoskop Heine Delta 30 K-230.28.305
Dermatoskop KaWe EUROLIGHT®
Kristalno jasne slike, bez obzira da li preferirate bližu ili daljnju radnu udaljenost. Polarizacija eliminira refleksije i odsjaje. Kontrola jačine svijeta u 3 nivoa. Jednostavno čišćenje pomoću dezinfekcijskih sredstava u aerosolu. Uvećanje 10x. Bez unakrsne kontaminacije: autoklavibilna kontaktna pločica sa skalom. Dioptrijska kompenzacija. Promjena iz polariziranog u ne polarizirani način rada pomoću samo jedne tipke. Punjiva Li-ion baterija bez memorijskog efekta, sigurno punjenje bez obzira na stanje baterije. Mala kontakta pločica za teško dostupna područja pigmentnih lezija.




Dermatoskop Heine mini 3000

Optika visoke kvalitete. Ksenonsko-halogena žaruljica daje koncentrirano, ravnomjerno bijelo svjetlo. Metalna glava instrumenta. Mogućnost korištenja sa sustavom drški mini 3000. Dodaci: baterije ‘AA’ od 2,5 V ili baterije koje se mogu puniti pomoću stolnog punjača mini NT. Visokokvalitetni optički sustav s akromatskim lećama pruža oštru, detaljnu sliku bez iskrivljenja s desterostrukim uvećanjem. 5 kontaktnih diskova za pregled: sa i bez skale, mogućnost steriliziranja u autoklavu. Posebni manji kontaktni disk (bez skale) za pregled lezija koje su teže dostupne. Detaljni dermatoskopski kompendij. Jednostavno održavanje.
01.9.3193.00 | XHL halogen
01.9.5697.00 | LED
Dermatoskop DermLite DL3N

Polarizirani i nepolarizirani mod rada (nepolarizirani za kontaktnu tekućinu). 28 snažnih LED žaruljica osiguravaju vrlo kvalitetnu iluminaciju. Objektiv: 25 mm leća s povećanjem od 10x. Čak 4 leće za smanjenje optičke distorzije i povećanje oštrine slike. Omogućuje kontaktne i bezkontaktne preglede. Dvije jačine iluminacije, veće vidno polje, poboljšana vizualizacija pigmentnih struktura unutar lezija (PigmentBoost™). Jednostavno magnetsko povezivanje, uz odgovarajući DermLite adapter, sa gotovo svim modelima pametnih telefona i tableta omogućuje jednostavno fotografiranje i pohranu. Punjiva Li-Ion baterija, indikator napunjenosti baterije s 4 razine. Komplet sadrži: kožnu torbicu, sjenilo za oko operatera, stolni punjač /stalak za dermatoskop.

Veliki kontaktni disk (fi 25 mm) sa skalom za mjerenje promjena pigmentacije kože, osobito prikladan za rano dijagnosticiranje malignih tumora. Ravnomjerno, intenzivno osvjetljenje. Robusna, metalna baterijska drška ‘C’, sklapanje na klik, torbica s patentnim zatvaračem, 250 ml Derma-Gela. Napajanje: 2 male baterije (nisu uključene). Halogena žaruljica, deseterostruko uvećanje. Podešavanje fokusa od -6 do +3,5 dioptrije.
Dermatoskop KaWe PICCOLIGHT®
01.9.2706.00 Šifra
01.9.2705.00
Veliki kontaktni disk (fi 25 mm) sa skalom za mjerenje promjena pigmentacije kože, osobito prikladan za rano dijagnosticiranje malignih tumora. Ravnomjerno, intenzivno osvjetljenje. Baterijska drška tipa ‘AA’, plastična, crna. Baterije: 2 ‘AA’ baterije od 1,5 V (nisu uključene), dodatak - platnena torbica. Vakuumska žaruljica. Deseterostruko uvećanje. Podešavanje fokusa od -6 do +3,5 dioptrije.

Dermatoskop DermLite 100
Šifra
01.9.5704.00

Bezuljni epiluminescentni dermatoskop. LED diode postižu intenzivno, prirodno osvjetljenje, uvećanje 10× pomoću. Hastingsove Triplet leće. Napredna tehnologija unakrsne polarizacije. Tehnologija “suhe” epiluminescencije tvrtke 3Gen i eliminacija staklene pločice pomažu. bolje vizualizirati telangiektazije koje se povezuju s ranim otkrivanjem karcinoma bazalnih stanica.
Dermatoskop DermLite Lumio
Šifra
01.9.5705.00
Daje dubinsku sliku kože bez odbljesaka: Pregled varikoznih vena, pigmentiranih kožnih lezija, folikula kose itd. Elegantan, ergonomski dizajn. Komplet sadrži: 1 uređaj Lumio, četiri baterije tipa “AA” i 1 zaštitnu neoprensku torbicu. Osvjetljenje: 40 LED dioda. Leća promjera 75 mm uvećava do 2 x. Unakrsna polarizacija. Napajanje: baterije tipa “AA” (vijek trajanja: 250 pregleda u trajanju od 30 sekundi).

Video kolposkop KN-2200 bez monitora
Šifra
01.A.5408.01
Video kolposkop KN-2200, inačica bez monitora, dolazi sa softverom uz mogućnost spajanja na osobno ili prijenosno računalo. Video kolposkop KN-2200 je sustav koji kombinira računalnu tehnologiju, digtialnu sliku i kolposkop. Namijenjen je za ginekološku upotrebu pregleda vagine, cerviksa i vanjskog dijela genitalija kao pomoć liječnicima u dijagnostici i odabiru područja biopsije. Napredna digitalna kamera,ginekološka upotreba. Višejezična programska podrška za korisnika. Prilagodljiv zeleni filter. Podesiva svjetlina. Brz automatski fokus i manualni fokus. Zoom: 35x. Podešavanje bijelog balansa na gumb. 1/4 inčna CCD kamera s LED hladnim izvorom svjetla. Podesivo mobilno postolje. Osvjetljenje: 1,200 luksa. Udaljenost rada: 200-400 mm.

Video kolposkop KN-2200 s monitorom ili LCD zaslonom
Šifra
01.A.5408.02
01.A.5408.03
Prikaz slike na LCD zaslonu ili monitoru (ovisno o modelu). Napredna digitalna kamera, ginekološka upotreba. Softver kompatibilan s Win7 i Win8 operativnim sistemom, višejezična programska podrška za korisnika. Uređaj ima mogućnost uvećavanja, zelenog filtera te ručnog podešavanja fokusa te svjetline pomoću ručnog upravljača. Brz automatski fokus i manualni fokus. Zoom: 35x. Podešavanje bijelog balansa na gumb. 1/4 inčna CCD kamera s LED hladnim izvorom svjetla. Podesivo mobilno uspravno postolje, lagano za pomicanje. Osvjetljenje: 1,200 luksa. Udaljenost rada: 200- 400 mm. Dodaci (za model s monitorom): kartica i program za povezivanje s računalom.
Kolposkop binokularni KN-2200B
Šifra
01.A.5410.00
Binokularni kolposkop s uspravnim postoljem laganim za pomicanje. Mogućnost povezivanja na računalo. Primjena u ginekologiji i opstetriciji. 1/3 inčna CCD kamera s automatskim fokusom. LED hladni izvor svjetla. Zeleni filter. Uređaj dolazi sa softverom dostupnim na kineskom, engleskom, španjolskom, ruskom, vijetnamskom i turskom jeziku. Podesiva svjetlina.Okulari: fokus 160 mm, ugrađeno precizno mjerilo. Povećanje okulara: 12.5x . Dioptrijsko namještanje okulara: dioptrije +/-5. Širokokutni, prilagođeni okulari za nositelje naočala. Mikrofokus: 0-40 mm. Radna udaljenost: 295 mm.Međuzjenična udaljenost: 50-75 mm. Optičko povećanje: 2.8-17x Osvjetljenje: max. 30.000 luxa.

Komplet za digitalno snimanje kolposkopije KN-2200B
Šifra
01.A.5409.00

01.A.5408.02 | monitor
01.A.5408.03 | LCD zaslon
Kolica, računalo i pisač nisu uključeni u ponudu.
Dvokanalni izvor svjetla s pet optičkih magnituda uvećavanja. Postolje s podesivim nosačem. Uređaj dolazi sa softverom dostupnim na kineskom, engleskom, španjolskom, ruskom, vijetnamskom i turskom jeziku. Komplet uključuje: priključak, CCD kameru, video kabel, USB priključak, računalni program. Kamera: 1/3 inčna CCD kamera s rezolucijom 480.000 px, gama korekcija i korekcija boja.
Računalni program: kompatabilan s Win7 i Win8, 32/64 bit. Mogućnost uređivanja spremljenih slika i usporedbe slika.
Tekstualni zapis: mogućnost unosa novih ili korištenje unaprijed unešenih tekstova.
Pisač nije uključen u ponudu.



Kolposkop Alpha YDJ-1 s fiksnim povećanjem od 10x
Šifra
01.a.5411.00
01.a.5412.00
01.a.5413.00
01.a.5414.00
Glava: nagnuta +/- 15 °, podesiva po visini i rotacija. Rotacija glave: 310 °. Hod svjetla glave 45 ° nagnut. Podešavanje udaljenosti oka: 55-75 mm. Podešavanje dioptrije na lijevom okularu: +/- 5D. Radna udaljenost : 200 mm. Okulari: WF 10x / 20 mm. Puno povećanje: 10x. Područje gledanja: 22 mm. Osvjetljenje: podesiva svjetlina, 2 x 2 W PowerLED, 4000K,> 50.000 luksa svjetlina. 650 x 650 mm s površinom poda, četiri kotačići (dva kočiva), lako se pomiču, metalni stalak. Težina stalka je 6 kg, + 7 kg, dodana je težina za povećanje stabilnosti. Maksimalno proširenje od okomite šipke: 430 mm. Zakretne točke na vijcima. Podešavanje okomitog raspona ruke plinske opruge: +/- 150 mm. Uključeno u paket: poklopac za prašinu, gumeni okular, DC. 12V, zidno napajanje, produžetak napajanja, korisnički priručnik. Cijene vrijede samo za kolposkop . Dodatak prikazan na slici može se naručiti zasebno.
Stalak za kolposkop
Alpha YDJ-1
Metalni stalak koji se lako pomiče s 4 kotačića (2 kočiva).


01.a.5412.00 | Stalak za kolposkop Alpha YDJ-1
01.a.5413.00 | Univerzalni set za montažu za Alpha YDJ-1 kolposkop
01.a.5414.00 | Adapter za pametni telefon za Alpha YDJ-1 kolposkop

Kolposkop Alpha YDJ-2 sa zum uvećanjem
Šifra
01.a.5421.00
01.a.5423.00
Kolposkopi serije YDJ II precizni su optički instrumenti dizajnirani posebno za ginekološki pregled i dijagnozu. Zbog povećanja, instrumentom se jasno vide patološke promjene u rodnici, koje je nemoguće vidjeti golim okom. Stoga je ispravnost dijagnoze značajno povećana. Kolposkopi YDJ II serije imaju oštru sliku, široko vidno polje, ujednačeno osvjetljenje, podesivu svjetlinu i jednostavani su uporabu.


Stalak za kolposkop Alpha YDJ-2
Težina stalka 23 kg, kolposkop ukupno. težina 30 kg. Opseg vertikalnog podešavanja sustava ruku na šipki: 400 mm. Baza: 460 x 460 mm s 2 kočena kotača.
Kolposkop Colpy
Šifra
01.A.3987.00
Binokularni kolposkop s halogenom žaruljom i mobilnim stalkom. Podesiva visina mobilnog stalka: 73 - 104 cm. Uvećanje: 6,2 ×, standardna leća s uvećanjem od 10 ×. Optički sustav: stereo, s mogućnošću podešavanja udaljenosti između zjenica od 48 mm do 77 mm. Podesiva optička glava na 45º. Osvjetljenje: halogena žarulja 12 V, 12 W. Radna udaljenost: 26 cm. Pregledno polje: 35 mm – 24 mm. Fokus: 36 mm, zeleni filter. Napajanje: AC. Težina: 5,2 kg.

Mikroskop Alpha ENT-1 i Alpha ENT-1F
Šifra
01.9.5741.00
01.9.5742.00
Pregledni mikroskop za uho, grlo i nos. Glava: binokular, ravni. Povećanje okulara: 12x , s podesivom dioptrijom +/-5D. Žarišna duljina objektiva: f 200 mm,f 300 mm. Zoom s 200mm lećom: Tri postavke uvećanja: 4.7x, 7.4x, 12x. Vidno polje: 40 mm, 25 mm, 16 mm. Fokus: 10 mm. Zoom s 300mm lećom: Tri postavke uvećanja: 3x, 5x, 8x. Vidno polje: 61 mm, 38 mm, 24 mm. Fokus: 10 mm. Osvjetljenje: 10W LED. Ugrađeni žuti i zeleni filteri. Glava podesiva u smjeru gore dolje. Podešavanje visine: 6001550 mm od poda, preporuka 1200mm. Pokretno postolje s pet kotačića od kojih se dva mogu fiksirati; mogućnost montiranja na zid ili stol (samo betonski ili cigleni zid). Napajanje: 12V. Dodaci: kabel za napajanje, vijak za podešavanje.

01.9.5741.00 | Alpha ENT-1
01.9.5742.00 | Alpha ENT-1F

Biomikroskop - slit-lampa HEINE HSL 150
Šifra
01.9.2564.00

Namijenjen za pregled prednjeg očnog segmenta u medicini i veterini. Kompaktan i lagan, prenosiv, idealan kada se ne može koristiti velika slit-lampa. Podesiva veličina proreza od 0,2×10 mm do 4×14 mm; šesterostruko uvećanje. Filter koji uklanja plavo svjetlo, prikladan za pregled rožnice. Višestruko obložena optika pruža maksimalni prijenos svjetla. Ksenonsko-halogena XHL tehnologija - žaruljice od 2,5 V proizvode intenzivno, bijelo svjetlo usporedivo s intenzitetom klasične slit lampe. Težina glave instrumenta HSL 150 iznosi samo 70 g, što lampu čini najlakšom lampom te vrste.
Profesionalni mikroskop Alpha ENT-4 i Alpha ENT-4C
Šifra
01.9.5733.00
01.9.5734.00
Alpha ENT-4C je model s integriranim sustavom videokamere. Ostale karakteristike mikroskopa su iste za modele Alpha ENT-4 i 4C. 2 godine jamstvo! Glava: binokular ravni. Žarišna duljina: f170 mm s ugrađenim finim fokusom. Ručno uvećanje u 5 koraka: 0.4x, 0.6x, 1.0x, 1.6x, 2.5x. Uvećanje: 3.5x, 5.4x, 8.5x, 13.5x, 21.2x (s objektivom f250mm i 12.5x okularom). Prilagođeni okulari za nositelje naočala. Povećanje okulara 12.5x, dioptrijsko namještanje okulara: dioptrije +7 do -7. Međuzjenična udaljenost: 48- 78 mm. Vidno polje: 65 mm, 42 mm, 26 mm, 10.4 mm (s objektivom f250mm i 12.5x okularom). Fokus: 12 mm, ručni. Izvor svjetla: 2 halogene lampe 150W/15V s optičkim kablom. Vidno polje: 50 mm (s objektivom f250mm). Ugrađeni žuti i zeleni filter, izmjenjivi. Napajanje: 240V 50 Hz, 60Hz. Stalak. Podno postolje s podesivom drškom u zglobu, pomak: +/- 300 mm. Max. dužina drške : 1100 mm (ne uključujući produžetak od 350 mm). Dodaci. Priključak za videokameru 1/3 col, razdjelnik širine snopa svjetlosti (50% ; 50%; 20%; 80%), priključak za digitalnu kameru, pridužetak drške od 350 mm.
01.9.5733.00 | Alpha ENT-4 01.9.5734.00 | Alpha ENT-4C

Routine Binocular mikroskop
Šifra BOE 1200.10

Binokularna glava, nagnuta za 30°, rotira za 360°. Međuzjenična udaljenost 55 - 75 mm. Par okulara sa širokim vidnim poljem WF 10x/18. 4 BOECO akromatska DIN objektiva: 4x/0.10; 10x/0.25; 40x/0.65, na opruzi; 100x/1.25, s uljem, na opruzi. Pločica za uzorke 140x140 mm. Podržava niže pozicije, koaksijalna kontrola grubog i kalibrirana kontrola finog fokusa. Gradacija: 2 mikrona. Ukupni raspon fokusa 24 mm, s autofokus stopom. Kondenzator Abbe Brightfield, n.A. 1,25. Halogena žarulja 6V 20W, moguće je prilagoditi intenzitet.
VIVO skener vena
Šifra
12.0.5893.00

Hemoglobin absorbira više infracrvene svjetlosti od okolnog tkiva, stoga se u osvjetljenom području vene prikazuju kao tamne linije. Ovom tehnologijom je vidljivo do 80% inače nevidljivih vena. IR osvjetljenje: 850 i 940 nm. Svjetlina je prilagodljiva. Rezolucija slike 856x480 px. Napajanje: na struju ili punjivu litijsku bateriju. Dim: 213x63x62 mm. Težina 430 g. Tri različita načina rada: osnovni, zeleno svjetlo i dubinska detekcija.
Dijagnostička svjetiljka, KaWe DIALIGHT® XL, crna
Prijenosni skener vena

Dijagnostička svjetiljka s plastičnom glavom te ksenonskom svjetiljkom daje izvrsnu svjetlinu potrebnu za većinu zahtjevnijih liječničkih pregleda. Svjetiljka je duga 13 cm, promjera glave 2 cm. Ksenonska žarulja jačine 2,5V - Napajanje: 2 “AA” baterije (nisu uključene u cijenu)
Dijagnostička svjetiljka CLIPLIGHT KaWe
Šifra
01.6.5353.01
01.6.5353.02
01.6.5354.01 Šifra

01.6.5353.03
01.6.5353.04
01.6.5353.05

Prijenosni infracrveni skener prikazuje sliku potkožnih vena na točnoj poziciji na koži. Udaljenost mjerenja: 29 - 31 cm. Snaga osvjetljavanja: 3001000 luksa. Valna duljina zrake: 750 - 980 nm. Napajanje: litij-ionska polimerna baterija. Težina: 280 g. Otpornost na vodu IPX0.
Prijenosni medicinski infracrveni skener vena
12.0.5895.00 Šifra
01.6.5353.06

Džepna dijagnostička svjetiljka izrađena od metala i prebojana jednom od šest različitih boja je neizostavan dodatak potreban pri gotovo svakom liječničkom pregledu. Lagana svjetiljka je duljine 13 cm, što znači da stane u svaki džep za koji se može i zataknuti. Uključivanje pritiskom na tipku sa strane - 2 baterije tipa “AAA”.
01.6.5353.01 | crna
01.6.5353.02 | crvena
01.6.5353.03 | žuta
01.6.5353.04 | plava
01.6.5353.05 | siva
01.6.5353.06 | lila

Otkriva površinske vene pomoću patentirane infracrvene tehnologije jasno prikazujući mrežu vena izravno na koži. Lagan proizvod džepne veličine koje se može lako držati u ruci, a isto tako i postaviti i na specijalizirani stalak ili fiksirati na stol. Ovaj uređaj omogućuje bezbolno vizualiziranje vena radi lociranja, procjene i venepunkcije čime pomaže pacijentima kod kojih je teško odrediti položaj vena, kao što su novorođenčad, osobe s pretilošću, edemom, ograničenom pokretljivošću te u hitnim situacijama.
VEIN EZ lampa za prikaz vena
ZD-JM-260-04 Šifra
12.0.5882.00
ZD-VEZ200 predstavlja mali LED uređaj koji pomaže razlikovati vene od okolnog tkiva. Za kućnu i kliničku uporabu, olakšava davanje injekcija. Posebice pogodan za starije pacijente i djecu. Prilagodljiva svjetlina. Napajanje: punjiva litijska baterija.



Dijagnostička svjetiljka bijele boje s nastavkom za depresor jezika

Dijagnostička svjetiljka džepnih dimenzija za medicinsku upotrebu. Sadrži nastavak za depresor jezika (depresor jezika nije uključen). Napajanje: 1,5V baterija (uključena). Boja: bijela.
Dijagnostička svjetiljka
01.6.0157.00
Dijagnostička svjetiljka napravljena od metala u bijeloj boji. Gumb za uključenje na vrhu. Uz svjetiljku dolaze 2 baterije tipa ‘AAA’ za napajanje.

Šifra
J-008.31.277
J-008.31.276

Šifra

Kompaktno LEDHQ čeono svijetlo – sada sa još više svijetla. Postoji LED i HEINE LEDHQ – postavljamo nove standarde, samo najbolje je dovoljno dobro, od izbora materijala do završne obrade. LED u HQ kvaliteti: novi standard u LED iluminaciji definira optimalni intenzitet osvjetljenja, homogenost i indeks boje za najtočniju dijagnozu. Kompaktna i lagana: osigurava odličnu komociju. Aluminijsko kućište. Štiti lampu od ulaza vlage i prašine te osigurava dugi radni vijek i optimalnu termalnu kontrolu. Koaksijalna iluminacija. Koaksijalni dizajn osigurava jasnu iluminaciju bez sjena i omogućava iluminaciju teško dostupnih mjesta. Homogenost. Potpuno jasna svijetla točka osvjetljenja koja je unificirana od ruba do ruba za perfektnu iluminaciju i za svaku preglednu situaciju. Zamjenjivi spojni kabl SC1. Zamjenjiv u slučaju potrebe sa visoko kvalitetnim konektorom koji je otporan na prskanje dužine 1,5 m. Spaja MicroLIght 2 sa baterijom. Uključivo kopčice u boji za personalizaciju. Služi za fiksiranje kabla i za lakšu identifikaciju Vašeg čeonog svijetla. Opcijski filteri. Polarizacijski filter P2 pojačava kontrast a žuti filter reducira plavo svijetlo.
Tehničke karakteristike:
• Iluminacija - do 55.000 Luxa
• Temperatura boje - 4,000 Kelvina
• Radni vijek LED diode - do 50,000 sati
• Veličina točke - Iluminacijsko polje je dizajnirano kako bi bilo u skladu s HR/ HRP lupama, 81 mm Ø na 420 mm, 95 mm Ø na 520 mm radnoj udaljenosti
• Težina - 80 gr. zajedno sa S-frame zaštitnim okvirom, 190 gr. sa Lightweight naglavom – bez lupa
• Kut deklinacije - Stepenasto i individualno podesiv za svaku potrebu
• Vrijeme rada - 9 sati sa mPack mini baterijom ( kod 100% osvjetljenja tipično 4 sata )
• Vrijeme punjenja baterije - Tipično 4 sata
• Dimenzije baterije - Kompaktna i lagana, težine 95 gr, dim. 44 x 23 x 101 mm
Čeono svjetlo Minston KS-W02
01.6.5365.00
Udobna prednja svjetla s mogućnošću zatamnjivanja s velikim kapacitetom baterije. Izvor svjetla: 1 x 5W LED. Svjetlina: 20.000-40.000 luxa. Radni vijek LED diode min 5.000 sati. Radni razmak: 200-500 mm. Kapacitet baterije: 1800mAh. Vrijeme punjenja do 100%: 2 sata. Vrijeme rada s 1 punjenjem: 20 sati pri minimalnoj svjetlini, 5 sati pri maksimalnoj svjetlini.

Najprodavanije čeono svjetlo za kirurške zahvate - savršeno pristajanje uz savršen pregled situacije tijekom dugih postupaka. Podesiva širina snopa osvjetljenja: raspon širine snopa od 30 mm do 80 mm (na radnoj udaljenosti od 420 mm) kako bi odgovarao svakoj situaciji pregleda. Jasno i homogeno osvjetljenje: potpuno jasna točka osvjetljenja, ujednačena od ruba do ruba za savršeno osvjetljenje svake pregledne situacije. Dobra kontrola intenziteta osvjetljenja: optimalno osvjetljenje kako bi se spriječila refleksija. Pristajanje po vašoj mjeri: HEINE ML4 LED čeono svjetlo opremljeno je meko podstavljenom trakom za glavu Professional L s više točaka podešavanja - udobnost i stabilnost čak i tijekom dugotrajnog nošenja. Model s ugrađenim transformatorom. Temperatura boje 4500K. Vjerodostojan prikaz boja. Podešavanje zrake svjetla od 30 do 80 mm (na udaljenosti od 42 cm). Aluminijska navlaka na spojevima održava svjetiljku hladnom. Visokoučinkovita LED HQ žarulja proizvodi jako, ravnomjerno svjetlo, bez stvaranja sjena. Osvjetljenje: 50 000 luksa na udaljenosti od 25 cm. Trajanje LED žarulje 50 000 sati. Fleksibilno podesiv kut osvjetljenja. Heine LED HQ žarulje imaju neograničen vijek trajanja i nije ih potrebno održavati.

Šifra
01.6.4409.00
01.6.2520.00
J-008.31.415 Šifra
Visokoučinkovita LED žarulja velike jačine proizvodi bijelo, ravnomjerno svjetlo prikladno za različite dijagnostičke postupke, npr. u stomatologiji i otorinolaringologiji. Temperatura boje 5500 - 6000 K. Aluminijska navlaka na spojevima održava svjetiljku hladnom. Podesiva osvjetljenost površine, zatvarač blende, kut osvjetljenja. Jednostavno i lako podešavanje trake za glavu pomoću unutarnjeg niveliranja, bez vijaka ispod držača. Moguća zamjena podstave. Trajanje LED žarulje 50 000 sati. Masa: 390 g (s baterijom). Podesiva širina zrake od 60 do 110 mm (na udaljenosti od 25 cm), od 120 do 240 mm (na udaljenosti od 50 cm). Osvjetljenje: 50 000 luksa. Punjenje baterije za traku za glavu: ~4,5 h. Punjenje baterije za remen: ~6 h. Trajanje baterije za traku za glavu: ~12h. Trajanje baterije za remen: ~24h. Vijek trajanja baterije: ~ 500 punjenja.


01.6.4409.00 | s baterijom za traku za glavu 01.6.2520.00 | s baterijom za traku za remen
Sedam super svijetlih LED žaruljica. Tri funkcije: 1 LED/3. LED/7 LED. Podesivi nagib, vodootporna. Napajanje: 3x“AAA” baterije (nisu uključene).


Lupe smanjuju naprezanje očiju i to uvećavanjem vidne slike prilikom rada sa sitnim predmetima ili pri obavljanju veoma preciznih operacija. Obično su lako prenosive te ih se lakše koristi od mikroskopa. Doduše, nisu sve lupe jednake, pa je veoma bitno znati odabrati par koji će Vam biti najprikladniji za rad. Odabir prikladne lupe uključuje nekolicinu čimbenika, poput rezolucije lupe, radne udaljenosti, vidnog polja, dubine, uvećanja, težine i razmaka zjenica. U idealnom slučaju, valja odabrati lupe s

Okular sa širokim vidnim poljem, 2,5x 340 mm sa zaštitnim naočalama. Duboki fokus za stereoskopski prikaz objekta. Kutovi lupe mogu se lako podesiti između 0° i 40° kako bi se smanjio zamor, čak i nakon dulje uporabe. 6 mm pomicanje gore-dolje. Podesiva udaljenost zjenica za različite tipove lica. Povećanje: 3,5x. Radni razmak: 340 mm. Vidno polje: Ø 60 mm. Težina: 140 g.
Čeono ogledalo Riester Clar N 55 LED, 6V

Čeono ogledalo Riester Clar N 55 LED, 6V je udobno za nošenje, jednostavno se namješta i skida. Ogledalo Ø 55 mm moguće je neograničeno podešavati i fiksirati a u kombinaciji s LED rasvjetom daje vrlo svijetlo i hladno svjetlo. Ogledalo ima ugrađen odjeljak za baterije s prekidačem a napaja se putem 2 litijske baterije veličine CR 123 A. Jednostavno čišćenje naglavne trake s odvojivim i perivim jastučićima. Bijela LED-žarulja od 1 W: temperatura boje: 4000° K, podesiv držač žarulje omogućava fokusiranje zrake svjetla.
najmanjim mogućim stupnjem primjenjivog uvećanja. U pravilu, što je manji stupanj uvećanja, to je veća dubina i vidno polje. Isto tako, što je veća radna udaljenost, to je vidno polje veće. Što je vidno polje veće, to manje morate zakretati glavu, što uvelike umanjuje naprezanje i umaranje. Isto tako je važna i težina lupe koja mora dobro pristajati na glavu. Lagane lupe su udobnije za dugoročno nošenje, te je šansa manja da Vam skliznu s nosa prilikom rada.

Sa zaštitnim naočalama. K-LED osvjetljenje(opcija). Homogeno svjetlo do 18 000 luksa. LED svjetlo od 3 W (opcija!) koaksijalno je pričvršćeno na okvir i radi na litij-ionsku bateriju (neprekidan rad do 4 sata). Dodaci: punjač, torbica, okviri, leće. Različite radne udaljenosti (34, 42, 46, 50 cm) i uvećanja (2,0x, 2,5x, 3,0x). Moguća nadogradnja lećama SuperVu Galilean. Primjena u urologiji, otorinolaringologiji, ortopediji i kirurgiji.

Sa zaštitnim naočalama. Povećanje: 3,5x. Radna udaljenost: 420mm. Prilagodljivi razmak zjenica pomoću jednog dodira.
Refleksni čekići KaWe Colorflex
Šifra
01.6.0072.07
Refleksni čekić po Trömneru
Dužina: 22 cm. Težina: 100 g
01.6.0072.07 | plavi
01.6.0072.08 | sivi


Šifra
01.6.1235.00
Refleksni čekić po Tromneru s crnom plastičnom drškom u kojoj se nalazi četkica te teškom glavom u kojoj se nalazi igla. Čekić je 23 cm visine te 200 grama težine.

Refleksni čekići
Refleksni čekić po Babinskyu
01.6.0072.08 Šifra
01.6.0950.00
Fleksibilna plastična drška. Izmjenjiva glava. Promjer glave 45 mm. Dužina: 23 cm. Težina: 70 g.

HEINE UniSpec® jednokratne tubeanoskop, proktoskop, rektoskop
Šifra
01.7.1654.00
01.7.1655.00
Šifra
01.6.0070.00
01.6.0074.00
01.6.1533.00
01.6.0070.00 | po Tayloru
01.6.0074.00 | po Bucku


01.6.1533.00 | po Berlineru po Tayloru

Komplet ligatora s glavom od 11 mm

01.7.3906.00
Širina 11 mm. 25 komada u paketu.

Jednokratne, eliminiraju mogućnost prijenosa infekcija. Ne zahtijevaju čišćenje, ušteda vremena. Izlivene iz za pacijente sigurne termoplastike, bez osjećaja hladnoće priikom umetanja. Prijenos svijetla preko stijenke tube, distalna anularna iluminacija. Svijetla, homogena iluminacija područja pregleda, bez refleksija. Graduacija unutar tube za komfor pacijenata, indikator duljine umetanja.
01.7.1654.00 | Anoskop, 25 kom. (E-003.19.925) - 85 × 20 mm
01.7.1655.00 | Proktoskop, 25 kom. (E-003.19.825) - 130 × 20 mm
01.7.2763.01 | Rektoskop, 25 komada (E-003.18.825) - 250 × 20 mm
HEINE UniSpec® iluminacijska glava za jednokratne tube
01.7.2763.01 Šifra
01.7.0121.00

Osvjetljenje bez odsjaja pomoću optičkog kabela te projektora, drške za svjetiljku ili BETA drške od 3,5 V s adapterom. Zoom povećala od 1,5 x stvara sliku visoke rezolucije. Izrađena od nehrđajućeg čelika. Pomični prozorčić za gledanje s nastavkom za insuflaciju. Namijenjen je za HEINE UniSpec® instrumente za jednokratnu upotrebu.
Gumeni prsten za ligator
01.7.3778.00
Bez lateksa. 100 komada u paketu.

Gumena pumpica za insuflaciju
01.7.1132.00

Za upotrebu s anoskopima, proktoskopima i sigmoidoskopima. Higijenski filter za jednokratnu upotrebu sprječava kontaminaciju pumpice.
Držač za spužvicu
01.7.1009.00

Vrhunski dizajn. Izrada od nehrđajućeg čelika. Duljina: 400 mm.

Rossmax zdravstvena stanica je sustav koji u jednom uređaju kombinira mjerenje krvnog tlaka, SpO₂ i arterijskog zdravlja, razine glukoze u krvi, upravljanje težinom i tjelesnom masnoćom te mjerenje temperature. Uređaj je prikladan za postavljanje u ljekarnama, klinikama, bolnicama, liječničkim ordinacijama, kao i na javnim mjestima poput fitness centara, sportskih klubova i trgovina. Također, odličan je izbor za domove za umirovljenike i staračke domove. Pruža korisnicima priliku za isprobavanje Rossmax Bluetooth uređaja i Rossmax Healthstyle aplikacije. Dostupan je u dvije verzije te dolazi standardno opremljen pisačem i kamerom. Opcionalno su dostupni NFC čitač, čitač pametnih kartica i skener bar koda. Na kraju mjerenja, korisnici dobivaju ispisanu potvrdu s QR kodom koji sadrži rezultate mjerenja i kontakt podatke.
Rossmax zdravstvena stanica za ljekarne, liječničke ordinacije i javne prostore
Funkcije:
• Mjerenje krvnog tlaka
• Praćenje razine SpO₂ i arterijskog zdravlja
• Praćenje razine glukoze u krvi
• Upravljanje težinom i tjelesnom masnoćom
• Mjerenje tjelesne temperature
DESKTOP verzija | 15,6«
Rossmax Health Station
Dolazi uz sljedeće uređaje:
• Tlakomjer X5 BT »PARR«
• Pulsni oksimetar s tehnologijom pregelda arterija SB210 »ACT«
• Mjerač glukoze u krvi HS200 BT
• Vaga s funkcijom mjerenja tjelesne masnoće WF262
• Beskontaktni telefoto toplomjer HC700 BT
Ispis potvrde mjerenja
Na kraju mjerenja korisnici dobivaju ispisanu potvrdu s QR kodom koji omogućuje pristup servisnom prozoru, kao i kod s rezultatima mjerenja. Ti rezultati mogu se dodati u aplikaciju Rossmax Healthstyle APP.
5-u-1
S aplikacijom Rossmax Healthstyle APP možete upravljati mjerenjima krvnog tlaka, glukoze u krvi, SpO₂, težine i temperature - sve na jednom mjestu. Proizvodi se jednostavno povezuju putem Bluetootha, omogućujući prijenos podataka u stvarnom vremenu jednim klikom. Mogućnost dijeljenja grafikona, prikaza i podataka s trećim stranama donosi novo iskustvo upravljanja zdravstvenim podacima.
Health Station
Health Station može se postaviti u ljekarnama i drugim javnim prostorima, čime privlači korisnike da isprobaju Rossmax Bluetooth uređaje (uključujući monitor krvnog tlaka, mjerač glukoze, pulsni oksimetar, termometar i monitor tjelesne masnoće) prije kup-

nje i učlanjenja u aplikaciju **Rossmax Healthstyle APP**. Dostupan je u dvije verzije te standardno dolazi s pisačem i kamerom. Opcionalno su dostupni NFC čitač, čitač pametnih kartica i skener bar koda. Na kraju mjerenja, korisnici dobivaju ispisanu potvrdu s QR kodom za kontakt sa servisom, kao i QR kod s rezultatima mjerenja.
Korisnička aplikacija
Aplikacija Rossmax Healthstyle APP pruža jasan pregled zdravstvenog stanja korisnika bilo kada i bilo gdje. Sinhronizacijom podataka putem Bluetootha, korisnici mogu lako pregledati povijest mjerenja za pet različitih Rossmax uređaja. Aplikacija također omogućuje dijeljenje mjerenja s trećim stranama.
Web-aplikacija
Inovativna aplikacija Rossmax Healthstyle APP nudi B2B korisnicima mogućnost upravljanja lokacijama trgovina, promocijama proizvoda i lokalnim događanjima, prilagođeno po državama, kroz jednostavnu web-platformu za administraciju.
Rossmax zdravstvena stanica dolazi u dvije verzije:
• DESKTOP verzija Rossmax zdravstvena stanica s 15,6" zaslonom osjetljivim na dodir
• DESKTOP verzija Rossmax zdravstvena stanica s 27" zaslonom osjetljivim na dodir (na upit)


Šifra
Profesionalni tlakomjer BP 500 lagan je i čvrst tlakomjer visoke točnosti koju postiže s dvostupanjskim mjerenjem tlaka.
Tehničke karakteristike:
• Lagan i čvrst s težinom manjom od 5 kg.
• Jednostavan i elegantan dizajn.

• Raspon mjerenja: tlak 30-300 mmHg, puls 30-240 bpm.
• Točnost rezultata mjerenja: tlak ± 2 mmHg, puls unutar ± 1,5%.
• Otkrivanje pokreta ruke tijekom mjerenja radi uklanjanja svake pogreške u mjerenju.
• Tlak mjeri čak i ako je ruka tanka ili je puls slab.
• Ocjenjivanje stanja krvnog tlaka pacijenta prvo u fazi napuhivanja, a drugo mjerenje u fazi ispuha.
• Izvrsna vidljivost uz jasan LCD.
• Tlakomjer je opremljen printerom za ispis rezultata mjerenja.

Profesionalni mjerni uređaj koji koristi oscilometrijsku metodu mjerenja. U potpunosti automatiziran, smanjuje vrijeme i opterećenje zdravstvenog osoblja prilikom mjerenja krvnog tlaka. Smješten, na primjer, u čekaonici odjela, poliklinike ili ljekarne, omogućuje pacijentu da samostalno izmjeri krvni tlak i preda isprintane rezultate medicinskom ili zdravstvenom osoblju. Opremljen velikim crvenim LED zaslonima za jasnu vizualizaciju sistoličkog, dijastoličkog tlaka i pulsa. Ugrađeni pisač omogućuje različite vrste izvješća o mjerenjima.
Tehničke karakteristike:
• Mjereni parametri: Krvni tlak, puls.
• Način mjerenja: Osmometrijski.
• Mjerni raspon: Tlak 0 – 299 mmHg, sistolički tlak 40 – 270 mmHg, dijastolički tlak 20 – 200 mmHg, puls 30 – 240 otkucaja/min.
• Pritisak: Automatski.
• Namjena: Odrasli.
• Točnost: Tlak ±3 mmHg, puls ±5%.
• Zaslon: Crveni LED.
• Dimenzije zaslona: Sistolički i dijastolički tlak – 2,6 inča, puls, sat i minute – 1,7 inča.
• Prikaz: Istodobni prikaz sistoličkog i dijastoličkog tlaka, pulsa, sata i minuta.
• Indikacije na zaslonu: Tijekom mjerenja: razine tlaka; Nakon
mjerenja: vrijednosti tlaka i pulsa, indikacija aritmije, kodovi pogreške, sat i minute.
• Unutarnja manžeta: Najlonska tkanina.
• Opseg primjene na gornjem udu: 18 do 35 cm.
• Sistem: Automatski s motorom.
• Ugrađeni pisač: Termalna glava.
• Širina papira: 58 mm.
• Napon: Mrežni, 220 V – 50 Hz.
• Bez lateksa: Da.
• Dimenzije: 241 x 390 x 324 mm.
• Potrošnja: 50 ~ 80 VA.
• Masa: 5,5 kg.
• Radna temperatura: +10 °C ~ +40 °C, relativna vlažnost 30% do 85%.
• Temperatura skladištenja: -20 °C ~ +60 °C, relativna vlažnost 10% do 95%.
Nova generacija profesionalnih digitalnih tlakomjera. Poboljšanog dizajna, pouzdaniji i robusnije konstrukcije u odnosu na prijašnju verziju. Rezultati mjerenja pojavljuju se u različitim bojama ovisno o stupnju hipertenzije. Mjeri sistolički i dijastolički tlak, puls i prikazuje PRP grafikon.
Tehničke karakteristike:

• Raspon mjerenja: tlak 30-300 mmHg, puls 30-200 otkucaja/minuti.
• Metoda mjerenja: Oscilometrijski.
• Zaslon: 7 inčni LCD zaslon u boji osjetljiv na dodir.
• Automatsko gašenje / paljenje prema senzoru udaljenosti.
• Integriran čitač kartica za praćenje i usporedbu rezultata.
• Glasovni vodič.
• Jednostavan rad pritiskom na jednu funkciju.
• Dimenzija: 463 (Š) x 324 (D) x 276 (V) mm.
Aneroidni uređaj za mjerenje krvnog tlaka.
Tehničke karakteristike:
• Vrlo precizan, nekorodirajući mehanizam manometra.
• Kromirano kućište otporno na udarce.
• Zaštita od prekomjerne inflacije.
• Promjer skale Ø 60 mm.
• Manžeta uključena (opseg ruke 27,5 cm- 36,5 cm, odrasli)
• Njemačka kvaliteta!
Dolazi u torbici za čuvanje. Iznimno izdržljiva manžeta (do 50.000 korištenja) s plastičnim prstenom. TPU tkanina, jednostavno čišćenje. Biokompatabilna manžeta prema DIN EN ISO 10993

02.3.5697.00 | MASTERMED A1+ Sfigmomanometar | 1 izvod
02.3.5706.00 | MASTERMED A2+ Sfigmomanometar | 2 izvoda

Tlakomjer Precisa® N Riester za mjerenje krvnog tlaka.
Tehničke karakteristike:
• Sadrži precizan ventil za ispuštanje zraka s finim podešavanjem.

• Mikrofilter tlakomjera štiti ventil za ispuštanje zraka te mjerni sustav.
• Dijafragma je posebno kaljena od legure bakra i berilija te gotovo da i ne zastarijeva.
• Kapacitet pritiska dijafragme: do 600 mm Hg.
• Materijal pumpice za napuhavanje manžete: lateks.
• Postolje ventila je metalno.
• Ergonomska drška u obliku žlice od nehrđajućeg čelika.
• Aluminijsko kućište.
• Skala ljestvice: od 0 do 300 mm Hg (lako čitljiva).
• Maksimalna tolerancija greške: +/- 3 mm Hg.
• Proizvedeno u Njemačkoj.
Precizan tlakomjer vrhunske Njemačke kvalitete sa integririranim stetoskopom.
Tehničke karakteristike:
• Posebno kaljena dijafragma od legure bakra i berilija, koja može izdržati opterećenje do 600 mm Hg

• Drška u obliku žlice izrađena od nehrđajućeg čelika
• Lako čitljiva linearna skala promjera 64 mm, od 0 - 300 mm Hg
• Maksimalna tolerancija pogreške: +/- 3 mm Hg
• Manžeta na čičak s metalnim prstenom i integriranim zvonom stetoskopa, 1 izvod
• Uključuje osobnu knjižicu za bilježenje krvnog tlaka
• Težina tlakomjera: 331 g
Riester RI-SAN tlakomjer sa Riester Duplex stetoskopom.
Tehničke karakteristike:
• Manžeta za odrasle s 1 izvodom
• Precizni ventil koji se može fino regulirati pritiskom prsta.
• Mikrofilter za dulju trajnost.
• Posebno kaljena dijafragma od legure bakra i berilija.

• Linearna skala promjera 64 mm, od 0-300 mm Hg.
• Opterećenje dijafragme do 600 mm Hg.
Riester R1 Shock- Proof tlakomjer dolazi u kompletu s velikom manžetom s jednim izvodom, bez lateksa, koja se može dezinficirati. Proizveden u Njemačkoj.
Tehničke karakteristike:
• Tlakomjer otporan na pad s visine od 1,20 m

• Posebno kaljena dijafragma od legure bakra i berilija
• Kapacitet opterećenja dijafragme- do 600 mmHg
• Najveća tolerancija pogreške mjerenja + - 3 mm Hg
• Mikrofilter štiti ventil za ispuštanje zraka i mjerni sustav
• Klinički validiran (BHS protokol), bez lateksa.
02.3.4411.01 | crni
02.3.4411.02 | bijeli
R1 Shock Proof Riester sfigmomanometarset
02.3.0399.00
02.3.5673.00
Riester R1 Shock - Proof set dolazi u kompletu s manžetom za djecu, manžetom za odrasle i ekstra velikom manžetom za odrasle s jednim izvodom, bez lateksa, koje se mogu dezinficirati.
Tehničke karakteristike:
• Proizveden u Njemačkoj
• Testovi su pokazali da je tlakomjer otporan na pad s visine od 1,20 m
• Skala bijela, promjera 52 mm
• Posebno kaljena dijafragma od legure bakra i berilija
• Kapacitet opterećenja dijafragme- do 600 mmHg
• Najveća tolerancija pogreške mjerenja + - 3 mm Hg
• Mikrofilter štiti ventil za ispuštanje zraka i mjerni sustav
• Klinički validiran (BHS protokol), bez lateksa
02.3.4411.01 | bez plastičnog postolja
02.3.4411.02 | s plastičnim postoljem

Šifra
02.3.1157.00
02.3.1118.00
Sfigmomanometar s velikim manometrom i lako čitjivom skalom. Dostupan u stolnoj i zidnij varijanti.
Tehničke karakteristike:
• Skala mjerenja krvnog tlaka do 300 mmHg
• Maksimalno dopušteno odstupanje od ±3 mmHg
• Velika košarica za manžetu
• Njemački projektirani ventil za ispuštanje zraka s finim podešavanjem
• Mikrofilter za zaštitu ispusnog ventila i mjernog sustava za sprječavanje kontaminacije unutarnjih mehanizama
• Atraktivan dizajn
• Visoka pouzdanost
• Odobreno od strane BIHS validacije


Šifra
02.3.5674.01
02.3.5674.02
02.3.2229.01
02.3.2229.02
Jednodijelna manžeta s jednim ili dva izvoda, bez lateksa, koja se da dezinficirati, za odrasle (opseg ruke 24-32 cm). Njemačka kvaliteta i točnost. Brzo napuhavanje manžete zahvaljujući novom ergonomskom dizajnu žlice.
Tehničke karakteristike:


• Ventil za ispuštanje zraka s finim podešavanjem

• Visoko polirana površina manometra, lako se dezinficira
• Veliki promjer skale O 63 mm
• Kapacitet opterećenja dijafragme - do 600 mmHg
• najveća tolerancija pogreške + - 3 mm Hg
• Kućište od polikarbonata koje štiti od udaraca
• Validacija po BHS protokolu, za kliničku uporabu
02.3.5674.01 (RI1376-151) | crna 2 izvoda
02.3.5674.02 (RI1371-151) | bijela 2 izvoda
02.3.2229.01 (RI1375-150) | crna 1 izvod
Šifra
02.3.1154.00
Ovaj je tlakomjer dizajniran posebno za djecu, sadrži 3 manžete različitih veličina (za novorođenče, dojenče i dijete).
Tehničke karakteristike:
• Ergonomična pumpica
• Precizno podesiv ventil
• Lako čitiljiva skala
• Membrana može izdržati pritiske do 600 mm
• Precizna linearna ljestvica, do 300 mmHg
• Granica dopuštenih pogrešaka +/- 3 mmHg
• Mikrofilter štiti ventil i sustav za mjerenje
• Dolazi u kompletu s torbicom sa zatvaračem
Šifra
02.3.0044.01

Bosch Sfigmomanometar
02.3.0044.02
02.3.0044.03
Precizni aneroidni sfigmomanometar njemačke kvalitete. Posebna manžeta vrhunske izrade. Kromirano kućište. Skala promjera 58 mm. Dostupne boje: crna, zelena, bordo.

02.3.2229.02 (RI1370-150) | bijela 1 izvod

Bosch Sfigmomanometar
Šifra
02.3.0043.01
02.3.0043.02
02.3.0043.03
Precizni aneroidni sfigmomanometar njemačke kvalitete. Posebna manžeta vrhunske izrade. Kromirano kućište. Skala promjera 50 mm. Dostupne boje: crna, zelena, bordo.

12.0.5391.00
Koristi se kada nije moguće mjerenje tlaka na nadlaktici.
Tehničke karakteristike:

• Precizna ručna pneumatska manžeta za mjerenje tlaka.
• Pritisak: 0-600 Hgmm.
• Kromirana pumpica i manometar.
• Za nadlakticu i bedro
Stolni sfigmomanometar
Aneroidni tlakomjer s četvrtastim kućištem.
Tehničke karakteristike:
• Lako čitljiva skala promjera 14 cm
• Čvrsta manžeta
• Skala: 0-300 mmHg

Šifra
WA-DS-5401-189CB
WA-DS-5521-129
Tlakomjer na pero s FlexiPort manžetom i torbicom. Precizan, čvrst i lagan model tlakomjera. Bez zupčanika, otporan na udarce i padove s visine do 76 cm.

Zahvaljujući DuraShock tehnologiji tlakomjer je otporan na padove te tlakomjer čini kalibriranim čak i uslijed udaraca i dalje ga čineći točnim i pouzdanim. Tlakomjer sadrži manžetu s čičkom koja odgovara opsegu nadlaktice 25-34 cm.
Tehničke karakteristike:
• Mjerno područje: 0 - 300 mmHg
• Točnost: +/- 3 mmHg
• Podjela mjerne skale: 2 mmHg
WA-DS-5401-189CB | DURASHOCK DS54 | bez lopatice
WA-DS-5521-129 | DURASHOCK DS54 | plava pumpica | s lopaticom

WA-DS-5401-189CB

Tlakomjer Heine »Gamma XXL«
M-000.09.322
M-000.09.323
M-000.09.325
M-000.09.326
Robusna polikarbonatna konstrukcija modernog dizajna otporna na teške uvjete i čestu upotrebu. Budući da GAMMA XXL ne sadrži živu, siguran je i ekološki prihvatljiv.
Tehničke karakteristike:
• Bez lateksa
• Izdržljiva konstrukcija od polikarbonata
• Velika vaga promjera 130 mm
• Duga spiralna cijev za napuhavanje (3 m)
• Indikator visoke kvalitete
• Precizni ventil za ispuštanje zraka
• Precizan i izdržljiv manometar koji ne zahtijeva održavanje
• Bez žive
• Stolni, zidni, klizno šinski i na stalku s kotačima




| klizno šinski M-000.09.326 | na stalku s kotačima
Klasični tlakomjer visoke kvalitete i preciznosti koji mjeri Korotkovljevom metodom.
Tehničke karakteristike:
• Raspon mjerenja: do 300 mmHg
• Ventil za ispuštanje zraka od mesingane ploče
• Igla za sprečavanje zaustavljanja
• Manžeta bez lateksa (pristaje obliku i opsegu ruke od približno 24 do 32 cm)
• Stetoskop je uključen uz proizvod

WA-DS-5501-189CB WA-DS-5521-129
Klasičan tlakomjer s manometrom renomiranog švicarskog proizvođača tlakomjera Rossmax.

Tehničke karakteristike:
• Izvanredne performanse i kvaliteta
• Veliki, lako čitljivi brojčanik od 65 mm
• Dovoljna je jedna ruka za mjerenje jer su pumpica i skala izrađene iz jednog dijela

• Pouzdani manometar s iglom sa sustavom za sprječavanje neželjenog zaustavljanja
• Manžeta bez lateksa (pristaje obliku i opsegu ruke od približno 24 do 32 cm)


KVANT UM TIM
Put u zdravu budućnost

S 616 - HR Broj servisa
Veliku pažnju poklanjamo servisu i održavanju uređaja koje prodajemo.

Servis je opremljen najmodernijim dijagnostičkim uređajima i jedan je od malobrojnih servisa u Hrvatskoj koji je certificiran za servis i ovjeru tlakomjera od strane Državnog zavoda za mjeriteljstvo Republike Hrvatske.
UMJERAVANJE ROSSMAX TLAKOMJERA GRATIS 100 %
Građani: UMJERAVANJE (BAŽDARENJE)
Liječnici: OVJERAVANJE OBIČNOG TLAKOMJERA
U DRŽAVNOM ZAVODU ZA MJERITELJSTVO
Ljekarne: OVJERAVANJE PROFESIONALNOG TLAKOMJERA
U DRŽAVNOM ZAVODU ZA MJERITELJSTVO
Ovjeravanje alkohol testera u Državnom zavodu za mjeriteljstvo
Ostale cijene formiraju se na bazi cjenika rezervnih dijelova i utrošenog vremena.
Vaš uređaj bit će pregledan i popravljen u najkraćem mogućem roku.
Radno vrijeme: ponedjeljak - petak od 8 do 16 sati
Kontakt: +385 1 36 37 453 servis@kvantum-tim.hr
Adresa: Kvantum-tim d.o.o., Voćarska 6a, 10437 Rakitje
U mogućnosti smo izvršiti popravak i umjeravanje većine tlakomjera (digitalnih i mehaničkih), a glavni smo uvoznici i servis za tlakomjere renomirane svjetske kompanije Rossmax.
VAŽNA NAPOMENA:
Sve uređaje koji nisu iz našeg prodajnog programa nećemo zaprimiti na servis bez prethodne telefonske najave. Na servis se možete najaviti putem sljedećeg telefonskog broja: 01 36 37 453.




UM TIM
Put u zdravu budućnost
Profesionalni tlakomjer za nadlakticu Rossmax X9
Nova generacija tlakomjera koja koristi PARR tehnologiju - rana detekcija aritmije (ARR), atrijske fibrilacije (AFib), preuranjene kontrakcije (PC), tahikardije (TACH) i bradikardije (BRAD).
Tehničke karakteristike:
• 2 godine jamstva
• Detekcija aritmije (ARR)
• Detekcija atrijske fibrilacije (AFib)
• Detekcija preuranjene kontrakcije (PC)
• Detekcija tahikardije (TACH)
• Detekcija bradikardije (BRAD)
• Dostupni i automatski i auskultatorni način mjerenja
• Detekcija manžete
• Detekcija pokreta
• Indikator rizika od hipertenzije

• 90 memorijskih mjesta s datumom i vremenom
• Uključene mala, srednja i velika manžeta
• Držač manžete
• Iznimno velike »XL« znamenke (LCD zaslona: 99x115 mm)
• LCD zaslon s pozadinskim osvjetljenjem
• Utikač za adapter
• Doživotna kalibracija

• Uključene tri veličine manžeta: mala (16 - 26 cm), srednja (24-36 cm) i velika (34-46 cm) manžeta.
Tlakomjer za nadlakticu »PARR« Rossmax Z5 | punjiva baterija| USB C priključak | Bluetooth
PRECIZNOST
Tlakomjer za nadlakticu »PARR« Rossmax X5
Tlakomjer zadnje generacije s Bluetooth® tehnologijom prijenosa podataka za spajanje s pametnim telefonima putem aplikacije.
Tehničke karakteristike:
• Bluetooth® tehnologija prijenosa
• 5 godina jamstva
• Detekcija aritmije (ARR)
• Detekcija atrijske fibrilacije (AFib)
• Detekcija preuranjene kontrakcije (PC)
• Detekcija manžete
• Indikacija pokreta tijela
• Indikator rizika od hipertenzije
• Prosjek zadnja tri očitanja
• Sedmodnevno »jutro-Noć« usrednjavanje (prosjek)

• 120 memorijskih mjesta za 2 korisnika s indikacijom datuma i vremena
• Mogućnost mjerenja za treću osobu - »Gost«
• Patentirana univerzalna stožasta manžeta bez lateksa
• Punjiva litij-ionska baterija
• Veliki LCD zaslon: 69x64,4 mm
• USB Type C port (USB priključak za napajanje)
• Doživotno kalibriranje

• Uz Z5 tlakomjer dolazi USB C kabel, manžeta, upute za korištenje i torbica sa zatvaračem
• Univerzalna manžeta pristaje opsegu nadlaktice: od približno 24 do 40 cm. Dostupne su i druge veličine na zahtjev.
Otkriva AFib (Detekcija atrijske fibrilacije) u ranoj fazi.
Tehničke karakteristike:
• 5 godina jamstva
• Detekcija aritmije (ARR)
• Detekcija atrijske fibrilacije (AFib)
• Detekcija preuranjene kontrakcije (PC)
• Detekcija manžete
• Detekcija pokreta
• Indikator rizika od hipertenzije
• Prosjek zadnja tri očitanja
• 120 memorijskih mjesta za 2 korisnika
s datumom i vremenom
• Mogućnost mjerenja za trecu osobu


• Patentirana univerzalna manžeta u obliku stošca bez lateksa
• Drzač manžete
• Veliki LCD zaslon: 69x78 mm
• Utičnica za adapter
• Doživotno kalibriranje
• Univerzalna manžeta pristaje opsegu nadlaktice: od približno 24 do 40 cm. Dostupne su i druge veličine na zahtjev
Tlakomjer za nadlakticu »PARR« Rossmax X5 BT | Bluetooth
Tlakomjer identičnih značajki kao X5, provjerene kvalitete s brojnim zadovoljnim korisnicam dobio je pojačanje u vidu Bluetooth® tehnologije za spajanje s pametnim telefonima preko aplikacije.
Tehničke karakteristike:
• Bluetooth® tehnologija prijenosa
• 5 godina jamstva
• Detekcija aritmije (ARR)
• Detekcija atrijske fibrilacije (AFib)
• Detekcija preuranjene kontrakcije (PC)
• Detekcija manžete
• Detekcija pokreta
• Indikator rizika od hipertenzije
• Prosjek zadnja tri očitanja
• Prosjek jutarnjih i večernjih očitanja kroz zadnjih 7 dana
• 120 memorijskih mjesta za 2 korisnika s datumom i vremenom


• Mogućnost mjerenja za treću osobu
• Patentirana univerzalna manžeta u obliku stošca bez lateksa
• Drzač manžete
• Veliki LCD zaslon: 69x78 mm
• Utičnica za adapter
• Doživotno kalibriranje
• Univerzalna manžeta pristaje opsegu nadlaktice: od približno 24 do 40 cm. Dostupne su i druge veličine na zahtjev.
Automatski tlakomjer na nadlakticu
Rossmax X3
Real Fuzzy tehnologija određuje
idealan tlak u manžeti na temelju vašeg sistoličkog krvnog tlaka i veličine ruke.
Tehničke karakteristike:
• Jamstvo 5 godina
• Detekcija pokreta
• Detekcija manžete
• Indikator rizika od hipertenzije


• Detektor nepravilnog rada srca (IHB)
• Prosjek zadnja tri očitanja.
• 120 memorijskih mjesta za 2 korisnika s datumom i vremenom
• Mogućnost mjerenja za trecu osobu (»gost«)
• Automatski rad pritiskom na jednu tipku
• Patentirana univerzalna manžeta u obliku stošca bez lateksa.
• Drzač manžete.
• Veliki LCD zaslon 57 x 73 mm
• Utičnica za adapter
• Doživotno kalibriranje
• Univerzalna manžeta pristaje opsegu nadlaktice: od približno
24 do 40 cm. Dostupne su i druge veličine na zahtjev.
Automatski tlakomjer za nadlakticu
Rossmax X1
X1 Rossmax tlakomjer donosi iznimnu pouzdanost i jednostavnost upotrebe.
Tehničke karakteristike:
• Doživotno besplatno kalibriranje
• 5 godina jamstva
• Real Fuzzy Tehnologija
• Detekcija pokreta
• Detekcija manžete
• Indikacija rizika od hipertenzije

• Patentirana stožasta manžeta bez lateksa
• Detektor nepravilnog rada srca (IHB)
• Samo jedan pritisak tipke potreban za rad
• Platnena torba za čuvanje uređaja
• Univerzalna manžeta pristaje opsegu nadlaktice: od približno 24 do 40 cm. Dostupne su i druge veličine na zahtjev.


Automatski tlakomjer za nadlakticu Rossmax Z1 | USB C priključak
Najnovija generacija Rossmax tlakomjera donosi iznimnu pouzdanost i jednostavnost upotrebe sada s USB-C priključkom pomoću kojeg tlakomjer može raditi i bez baterija - sve što Vam je potrebno jest USB-C kabel).
Tehničke karakteristike:
• Prikaz izmjerenog sistoličkog i dijastoličkog tlaka
• Broj otkucaja srca u minuti
• Indikacija pokreta tijela
• Real Fuzzy Tehnologija
• Indikator rizika od hipertenzije (HRI)
• Indikacija nepravilnog rada srca (IHB)
• Očitani rezultati - sve brojke i grafike - su velike te ih je lako očitati na ekranu veličine 69 x 64,4 mm


• 90 memorijskih mjesta, prosjek zadnja tri očitanja
• Samo jedan pritisak tipke potreban za rad
• USB-C priključak, 4 x AAA baterije (dolaze uz uređaj)
• Torba za čuvanje uređaja
• Patentirana manžeta bez lateksa, univerzalna
• Manžeta pristaje obliku i opsegu ruke od 24 do 40 centimetara
• Doživotno besplatno kalibriranje i 5 godina jamstva
• Univerzalna manžeta pristaje opsegu nadlaktice: od približno 24 do 40 cm. Dostupne su i druge veličine na zahtjev.
Tlakomjer za zapešće Rossmax S-150
Automatski tlakomjer za zapešće s napred nim sistemom kontrole zraka, indikatorom ri zika hipertenzije, nepravilnog srčanog ritma, 90 memorija i opcijom automatskog mjerenja pritiskom jedne tipke. Idealan za osobe koje provode puno vremena putujući.
Tehničke karakteristike:
• Tehnologija Smart Sense
• Detekcija pokreta
• Indikator rizika od hipertenzije


• Detekcija nepravilnog srčanog ritma (IHB)
• Klinički validiran
• Prosjek posljednja tri čitanja
• Automatski rad na jednu tipku
• 90 memorijskih mjesta

• Manžeta pristaje opsegu zapešća: od približno 13,5 do 22 centimetra
Automatski tlakomjer za nadlakticu Novama PRO
Šifra
TOW019578
Tlakomjer za nadlakticu s funkcijom otkrivanja fibrilacije atrija
Tehničke karakteristike:
• Dva načina mjerenja
• Otkrivanje fibrilacije atrija
• Nježno i brzo mjerenje tijekom napuhavanja
• Pokazatelj aritmije
• ESH validacija
• Tumačenje rezultata prema WHO-u
• Srednje vrijednosti iz 3 mjerenja
• 2 x 90 memorijskih mjesta
• Odobren za uporabu tijekom trudnoće
• Univerzalna manžeta visokog standarda (22 ~ 42 cm)
• Tamno plava pozadinska rasvjeta, kontrastni zaslon, velike osvijetljene brojke
• Uključen stalak za tlakomjer s držačem za manžetu
• 5 godina jamstva

PRECIZNOST PROVJERENA OD STRANE STRIDE BP
Automatski tlakomjer za nadlakticu Novama COMFORT X AF
Šifra
TOW015359
NOVAMA COMFORT X AF tlakomjer s inovativnim načinom brzog i jednostavnog postavljanja manžete Easy Cuff X.
Tehničke karakteristike:
• Memorija veličine 90 mjerenja za 2 korisnika omogućava praćenje tlaka kod dvije osobe.
• Uz uređaj dolazi dnevnik mjerenja tlaka
• Univerzalna manžeta za nadlakticu za opseg ruke od 22 - 42 cm omogućava precizno mjerenje i idealna je za većinu korisnika.

• Prikaz prosjeka rezultata 3 mjerenja
• Detekcija fibrilacije atrija, aritmije, preuranjene kontrakcije (PC), nepravilnog rada srca (IHB), stupnja hipertenzije
• Raspon mjerenja: Sis: 60-260 mmHg; Dia: 40-199 mmHg
• Preciznost mjerenja: ± 3 mmHg
• Raspon mjerenja pulsa: 40 - 180 otkucaja u minuti, ± 5%
• Automatsko isključivanje
• Napajanje putem 4 x AAA baterija
• U pakovanju tlakomjera dolaze: tlakomjer, Easy Cuff X manžeta s kopčom za lako postavljanje za opesg nadlaktice od 22 - 42 cm, 4 AAA baterije, upute za korištenje, dnevnik mjerenja krvnog tlaka i torbica za pohranu
Rossmax manžete
Šifra
BP_CF_003_RM Mala | Opseg nadlaktice 18 - 26 cm
BP_CF_002_RM Srednja | Opseg nadlaktice 24 - 36 cm
BP_CF_001_RM Velika | Opseg nadlaktice 34 - 46 cm
BP_CF_004_RM Univerzalna | Opseg nadlaktice 24-40 cm
Manžeta s dva izvoda, Italy, na čičak
Šifra Opis
02.3.2556.00 Za novorođenčad (4-11cm)
02.3.1346.00 Za bebe (8-15 cm)
02.3.1304.00 Za djecu (13-20 cm)
02.3.1303.00 Za odrasle (22-32 cm)
02.3.0959.00 Velika (25-40 cm)
Manžeta s dva izvoda, Bosch/Riester
Šifra Opis
02.3.0051.05 Za novorođenčad (4-11cm)
02.3.1111.02 Za bebe (8-15 cm)
02.3.0051.03 Za djecu (13-20 cm)
02.3.0051.02 Za odrasle (22-32 cm)
02.3.1143.02 Velika (25-40 cm)
Manžeta s jednim izvodom, Italy, na čičak
Šifra Opis
02.3.2555.00 Za novorođenčad (4-11cm)
02.3.0456.00 Za bebe (8-15 cm)
02.3.0426.00 Za djecu (13-20 cm)
02.3.0054.00 Za odrasle (22-32 cm)
02.3.1315.00 Velika (25-40 cm)
Manžeta s jednim izvodom,Bosch/Riester
Šifra Opis
02.3.0051.04 Za novorođenčad (4-11cm)
02.3.1111.01 Za bebe (8-15 cm)
02.3.0051.06 Za djecu (13-20 cm)
02.3.0051.01 Za odrasle (22-32 cm)
02.3.1143.01 Velika (25-40 cm)
Rezervni dijelovi za tlakomjere
Šifra Opis
BP_AD_002_RM Adapter za Rossmaxove tlakomjere BP_UC_001_00 Kabel za prijenos podatakaa
02.3.0050.00 Gumena pumpica s ventilom
02.3.0980.00 Standardni metalni ventil za pumpicu
02.3.1854.00 Riester gumena pumpica
Beskontaktni
Omogućuje mjerenje s udaljenosti od 10 cm, te veću točnost i ponovljivost mjerenja. Mjeri temperaturu tijela na sljepoočnici, kao i temperaturu predmeta.
Tehničke karakteristike:
• Telefotografsko mjerenje temperature od 10 cm udaljenosti
• Mjerenje u jednoj sekundi
• Mjerenje temperature na sljepoočnici
• Mjerenje temperature predmeta
• Zvučni alarm u slučaju vrućice
• 9 memorijskih mjesta
• Mjerenje u °C ili °F
• Pozadinsko osvjetljenje
• Automatsko isključivanje
• Indikator istrošenosti baterije
• Samoprovjera kvara
• 5 godina jamstva

Infracrveni toplomjer za čelo i uho koji govori hrvatski
Mjerenje temperature s KF-HW-003 toplomjerom može se vršiti na čelu ili u uhu (jednostavno maknite zaštitni pokrov sonde kako biste otkrili lijevak za ušno mjerenje).
Tehničke karakteristike:

• Visokoprecizni senzor infracrvenih zraka koji stabilno i pouzdano radi
• Dobra prilagodljivost na okolišnu temperaturu
• Automatsko memoriziranje zadnje izmjerene vrijednosti
• Velik zaslon s jakim pozadinskim osvjetljenjem i jasnim prikazom
• Automatsko isključivanje za uštedu energije
• Može pohraniti 50 nizova mjernih podataka za lakšu analizu i usporedbu
• Toplomjer na hrvatskom jeziku govori vašu trenutnu temperaturu
Toplomjer
Infracrveni ušni toplomjer s mjerenjem temperature u jednoj sekundi. Pogodan je za odrasle, djecu i bebe. Alarm za vrućicu. Devet memorija.
Tehničke karakteristike:
• Mjerenje u jednoj sekundi ili kontinuirano praćenje
• Mjerenje temperature u uhu
• Alarm za vrućicu
• 9 memorijskih mjesta
• Moguće mjerenje u °C i °F
• Poklopac sonde PLUG & SECURE
• Pozadinsko osvjetljenje
• Automatsko isključivanje
• Indikator istrošenost baterije
• Samodijagnoza u slučaju kvara

• 5 kapica u pakovanju, ostale se kupuju odvojeno
• 5 godina jamstva

Beskontaktni infracrveni toplomjer koji mjeri temperaturu na sljepoočnici u jednoj sekundi. HA-500 je naš najpopularniji beskontaktni toplomjer, a posebno je pogodan za bebe i malu djecu.
Tehničke karakteristike:
• Mjerenje na udaljenosti unutar 5 cm
• Mjerenje u jednoj sekundi
• Mjerenje temperature na sljepoočnici
• Mjerenje temperature prostora i predmeta
• Alarm za vrućicu
• 9 memorijskih mjesta
• Moguće mjerenje u °C i °F
• Pozadinsko osvjetljenje
• Automatsko isključivanje
• Indikator istrošenost baterije
• Samodijagnoza u slučaju kvara
• 5 godina jamstva


Infracrveni toplomjer za čelo
Infracrveni beskontaktni toplomjer YI-400 mjeri tjelesnu temperaturu otkrivanjem intenziteta infracrvene energije koju čelo isijava bez obzira na sobnu temperaturu.
Tehničke karakteristike:

• Mjerenje temperature na čelu (opcija Body) - klasično beskontaktno mjerenje temperature djece i odraslih na čelu
• Mjerenje temperature predmeta (opcija Object) - pomaže u praćenju je li temperatura predmeta prikladna za djecu ili odrasle
• Mjerenje temperature u 1 sekundi
• 32 memorijska mjesta za pohranu izmjerene temperature
• Zvučna i svjetlosna obavijest o visokoj temperaturi - kod temperature veće od 38°C
S jedinstvenom Age Precision® tehnologijom koja olakšava i pomaže roditeljima u interpretaciji izmjerene tjelesne temperature ovisno o dobi djeteta.
Tehničke karakteristike:
• Noćno osvjetljenje zaslona
• Memorira zadnjih 9 mjerenja


• Higijenske jednokratne kapice - bez lateksa i BPA (21 komad)
• Zaštitna plastična kutija
Digitalni toplomjer s čvrstim vrhom Rossmax TG100
Za oralnu, rektalnu i pazušnu uporabu.
Tehničke karakteristike:
• Mjerenje u 60 sekundi
• Alarm za vrućicu
• Automatsko isključivanje
• Moguće mjerenje u °C i °F
• Indikator istrošenost baterije
• Samodijagnoza u slučaju kvara
• 5 godina jamstva

Klinički stakleni toplomjer bez žive s praktičnom drškom za protresanje
Klasični stakleni toplomjer s lako čitljivom skalom u Celzijevim stupnjevima (°C). Dolazi u kutiji od otporne prozirne plastike uz čvrstu dršku za olakšano protresanje »leptirić«.
Tehničke karakteristike:
• Precizan toplomjer

• Lagan za korištenje s jasnom i čitljivom skalom
• Ekološki - umjesto žive koristi mješavinu galija i indija

Digitalni toplomjer sa čvrstim vrhom
Digitalni toplomjer s čvrstim vrhom za što ugodnije mjerenje temperature. Namjenjen je za oralnu, rektalnu i podpazušnu uporabu.
Tehničke karakteristike:
• Brzo i precizno mjerenje unutar 60 sekundi.
• Zvučni signal za kraj mjerenja.
• Alarm za visoku temperaturu (iznad 37.8°C).
• Vodootporan

Digitalni toplomjer sa fleksibilnim vrhom
Digitalni toplomjer s fleksibilnim vrhom Rossmax TG 380
Digitalni toplomjer s fleksibilnim vrhom za što ugodnije mjerenje temperature. Namjenjen je za oralnu, rektalnu i podpazušnu uporabu.
Tehničke karakteristike:
• Brzo i precizno mjerenje unutar 60 sekundi.
• Zvučni signal za kraj mjerenja.
• Alarm za visoku temperaturu (iznad 37.8°C).
• Vodootporan

Vodootporni digitalni toplomjer za oralnu, rektalnu i pazušnu uporabu.
Tehničke karakteristike:
• Mjerenje u roku 10 sekundi
• Alarm za vrućicu
• Automatsko gašenje
• Mjerenje u °C ili °F
• Pokazatelj slabe baterije
• Samoprovjera kvara
• 5 godina jamstva

Digitalni toplomjer s velikim ekranom i fleksibilnim vrhom | za starije osobe
Vodootporan toplomjer s fleksibilnim vrhom za oralno, rektalno ili podpazušno mjerenje.
Tehničke karakteristike:
• Mjerenje temperature unutar 10 sekundi.
• Veliki LCD ekran
• Točnost: ±0.1 (±0.2)
• Alarm za visoku temperature
• Fleksibilni vrh toplomjera
• Vodootopran
• Indikator slabe baterije.
• Automatsko gašenje.

Termometar - vanjski i unutarnji |
Temperaturna skala u rasponu od -32°C do +50°C smještena na drvenoj daščici u boji javora i trešnje. Za mjerenje vanjske i sobne temperature.

Termometar za mjerenje vanjske temperature
Termometar za mjerenje vanjske temperature.

Audiometri
Audiometar 600-M
Šifra
02.1.5650.00
Jednostavno povezivanje na računalo, prijenosan uređaj, interaktivan i intuitivan računalni program. Automatski i ručni način rada. Izrada baza, kartice pacijenta, spremanje i ispis podataka. Pomaže u tumačenju audiograma. Određivanje praga sluha po Hughson-Westlake metodi. Određivanje razine oštećenja sluha. Kontinuirani ili pulsirani zvuk. Frekvencije: 125, 250, 500, 750, 1000, 1500,2000, 3000, 4000, 6000, 8000 Hz (+/-2 %). Intenzitet zvuka (izlaz) između -10 i 100 HLdb. Slušalice: HD 428. Prijenos podataka / napajanje: USB link. Dimenzije: 92x150x28 mm, 1.3 kg; kofer: 280 x 310 x 100 mm; 160 g. Pribor: audiometar, kofer, slušalice s izvanrednom izolacijom, USB kabel, praćenje pacijenta, računalni program.
Audiometar 9910
Šifra



Audiometar SA-7
Šifra
02.1.5395.00
02.1.2559.00

Mali audiometar sa zaslonom osjetljivim na dodir, s memorijom i priključkom koji omogućuje spajanje na vanjsko računalo. Grafički zaslon u boji rezolucije 320×240 px. Nečujna tipkovnica uređaja neće omesti postupak ispitivanja. Snimljeni audiogram prikazan je na zaslonu. Prag sluha određuje pacijent, a njegov odgovor uređaj automatski bilježi u obliku dvije vrijednosti (frekvencija i intenzitet) praga sluha, a korisnik može poništiti rezultat mjerenja. Slušalice Peltor koje su odlično zvučno izolirane omogućuju dobro mjerenje sluha čak i u bučnom okruženju. Uređaj je jednostavan za uporabu. Automatsko mjerenje koje se zasniva na odgovoru pacijenta. MELODYTEST® pogodan je za mjerenje sluha djece. Korisnik ima mogućnost podešavanja najprikladnije vrijednosti raspona frekvencije te “reverzni” način rada. Frekvencije, intenzitet zvuka: 250 - 8000 Hz. Podešavanje u koracima od 5 dB. Automatsko određivanje praga sluha. Funkcija spremnja rezultata mjerenja za 50 pacijenata. Priključak za računalo: RS-232 serijski ulaz. Slušalice: TDH 39 (100 W), THD < 0,5%. Dimenzije: 157×92×35 mm. Težina: 0,45 kg.
02.1.2029.00 | Praćenje pacijenta za SA-7
02.1.2559.00 | Softver za SA-7 i SA-52

Timpanometar Amplivox Otowawe
Šifra
Digitalni audiometar tipa 4 omogućuje jasno postavljanje dijagnoze sluha. Jednostavno podešavanje frekvencije i jačine izravno na uređaju. 11 frekvencija, raspon od 125 do 8000 Hz (+/- 1%). Intenzitet od -10 dB do 100 dB, podešavanje u koracima od 5 dB. Prikaz frekvencije i intenziteta na dvostrukom velikom LCD zaslonu s pozadinskim osvjetljenjem. Vrsta tona: kontinuirani ili pulsirajući. Tihe, reljefne tipke kojima se upravlja ručno. Uređaj se automatski isključuje ako se ne koristi 3 minute. Sukladan Europskoj direktivi CE 0459. Dodatna opcija: mjerenje vremena odaziva. Isporučuje se u prijenosnom koferu otpornom na udarce koji sadrži: visoko zvučno izolirane slušalice Sennheiser, priključak za struju, korisnički priručnik. Težina: 1,5 kg. Dimenzije: 280 x 310 x 100 mm.
Audiometar Auditest
02.1.5654.00 Šifra
02.1.5655.00

Prijenosni i lagani audiometar, jednostavan za rukovanje koji za testiranje koristi zvuk preko slušalica. 11 frekvencija, raspon od 125 do 8000 Hz. Intenzitet od -10 dB do 100 dB, podešavanje u koracima od 5 dB. Vrsta tona: kontinuirani ili pulsirajući. Velik i lako čitljiv LCD zaslon. Korisnik ima mogućnost podešavanja najprikladnije vrijednosti raspona frekvencije. Odvojeno se može ispitivati sluh za lijevo i desno uho. Sukladan Europskoj direktivi CE 0459 i EN 60645-1. Ručna kontrola i automatsko isključivanje uređaja. Visoko zvučno izolirane slušalice Sennheiser. Baterije: 2 x 1,5 V. Dimenzije: 79 x 122 x 33 mm. Težina: 600 g. Isporučuje se u kutiji s uređajem, dvije baterije i CD-om s uputama.

Prijenosni, ručni timpanometar za brzu i točnu dijagnozu srednjeg uha. Ergonomski, lagan i elegantnog dizajna slijedi konture dlana uz odličnu raspodijelu težine. Nema vanjskih žica i kablova što ga čini prenosivim i lako operabilnim u svakom trenutku. Veliki grafički zaslon omogućava laku preglednost rezultata. Intuitivan za korištenje, prikazuje informacije prije, za i poslije testa kojeg provodi u trenutku. Timpanometar se može spojiti na računalo i pisač. Rezultati mjerenja za 30 pacijenata mogu se prebaciti na PC putem IrDA porta.
Timpanometar
02.1.5523.00 Šifra

Ručni timpanometar je lagan i kompaktan uređaj dizajniran za jednostavno, brzo i točno mjerenje skrininga srednjeg uha. Raspon tlaka: +200 do -400 daPa. Memorija: 50 pacijenata. Vrsta zaslona: s grafičkim zaslonom osjetljivim na dodir u boji. Veličina zaslona: 2,8 ”/ 43,2 x 57,6 mm. Rezolucija: 240 x 320 piksela. Napajanje: litij-ionska punjiva baterija. Trajanje baterije s 1 punjenjem:> 4 sata neprekidne upotrebe. PC sučelje: USB. Dimenzije: 65 x 44 x 240 mm. Težina: 340 g.
Pisač za timpanometar
02.1.5660.00 Šifra
02.1.5524.00

SIBELSOUND DUO je 2-kanalni audiometar, u skladu s Europskom direktivom o medicinskim uređajima i najvišim standardima kvalitete Prijenosne i lagane značajke SIBELSOUND DUO čine uređaj idealnim za izvođenje audiometrije u bilo kojem okruženju. SIBELSOUND DUO može se spojiti na audiometrov W50 softver putem USB-a, što korisniku omogućuje pregled, pohranu, prijenos i analizu audiometrijskih testova.

Tehničke karakteristike:
• Tip Audiometra: Screening
• Zračna vodljivost: »125 - 250 - 500 - 750 - 1000 - 15002000 - 3000 - 4000 - 6000 - 8000«
• Dimenzije: 236 x 197 x 77 mm
• Težina: 600 g
• Ekran: Color touchscreen
• Interna baza podataka: 1000 > testova
• Napajanje: »Vanjsko napajanje (100-240V)
Baterije: 4 AA 1.5V ili 4 Ni-MH«
• Standardni pribor: USB kabel, W50 demo mode software, Patient response button, DD45 slušalice, Prijenosna torba, Naponski adapter
Tehničke karakteristike:
• Tip Audiometra: Dijagnostički
• Maskiranje: Narrow Band Noise
• Zračna vodljivost: »125 - 250 - 500 - 750 - 1000 - 15002000 - 3000 - 4000 - 6000 - 8000«
• Koštana vodljivost: »125 - 250 - 500 - 750 - 1000 - 15002000 - 3000 - 4000 - 6000 »
• Dimenzije: 236 x 197 x 77 mm
• Težina: 600 g
• Ekran: Color touchscreen
• Interna baza podataka: 1000 > testova
• Napajanje: »Vanjsko napajanje (100-240V)
Baterije: 4 AA 1.5V ili 4 Ni-MH«
• Standardni pribor: USB kabel, W50 demo mode software, Patient response button, DD45 slušalice, Koštani vibrator B71W Prijenosna torba, Naponski adapter
Za upotrebu u audiometriji, esteziometriji i drugim dijagnostičkim postupcima.
komplet zvučnih vilica
Uključene zvučne vilice:
C 128 hz, s pričvršćenim prigušivačima
C1 256 hz, s pričvršćenim prigušivačima
C2 512 hz, bez prigušivača
C3 1024 hz, bez prigušivača
C4 2048 hz, bez prigušivača.

Spirometrija je jednostavna i bezbolna dijagnostička metoda. Ona je osnovni test u procjeni funkcije pluća. Spirometrija ne traje dugo, bezbolna je i ekonomski prihvatljiva, ali traži potpunu suradnju pacijenta i tehničara koji sudjeluje u izvođenju testa, budući da rezultat ovisi o kvaliteti napravljene pretrage. Nezaobilazan je u dijagnostici i praćenju bolesti dišnih putova, ali i niza drugih bolesti. Daje nam uvid u mogućnost postojanja opstruktivnih i/ili restriktivnih smetnje ventilacije.
Spirodoc
Šifra
910600E1
910610E1
• Višenamjenski
• 6MWT, Test spavanja, 24-satni Holter za SpO2%
• Zaslon osjetljiv na dodir

Spirodoc je višenamjenski prijenosni spirometer s zaslonom osjetljivim na dodir i opcionalnom 3D oksimetrijom. Osim spirometrijskih testova i spot oksimetrijskih testova, Spirodoc također omogućuje izvođenje 6-minutnog testa hodanja (6MWT), testova spavanja i 24-satnih Holter testova s opcijom 3D oksimetrije. Kako bi dodatno olakšao oksimetrijsko testiranje, Spirodoc je dizajniran s uklonjivim optoelektroničkim čitačem za spirometriju. Uz triaksijalni akcelerometar, moguće je snimiti kretanje i položaj pacijenta tijekom mjerenja. Uređaj omogućuje prikaz spirometrijskih testova u stvarnom vremenu, kako izravno na zaslonu uređaja, tako i na zaslonu računala putem namjenskog MIR Spiro softvera. Radi u oba načina rada, samostalno ili povezan s računalom putem USB kabela. Usklađenost s najnovijim smjernicama i međunarodnim standardima za spirometriju (ATS/ERS 2005 + ažuriranje iz 2019.; ISO 23747:2015; ISO 26782:2009), oksimetriju (ISO 80601-2-61:2017) i mnogim drugim.
Parametri spirometrije:
FVC, FEV1, FEV1/FVC%, PEF, FEV3, FEV3/FVC%, FEV6, FEV1/FEV6%, FEF25, FEF50, FEF75, FEF2575, FET, EVol, ELA, FIVC, FIV1, FIV1/FIVC%, PIF, VC, IVC, IC, ERV, FEV1/VC%, TV, VE, RR, tI, tE, tI/tTot, VT/tI, MVV
Tehničke karakteristike:
Tehničke specifikacije spirometra:
• Sonda: digitalna bidirekcijska turbina
• Raspon protoka: ±16l/s
• Točnost volumena: ±3% ili 50ml (veća vrijednost)
• Točnost protoka: ±5% ili 200ml/s (veća vrijednost)
• Dinamički otpor pri 12 l/s: <0.5cmH2O/l/s
• Temperaturni senzor: semikonduktor (0-45°C)
• Parametri spirometrije: FVC, FEV1, FEV1/FVC%, FEV3, FEV3/FVC%, FEV6, FEV1/FEV6%, PEF, FEF25%, FEF50%, FEF75%, FEF25%75%, FET, Estimated Lung Age, Extr. Vol., FIVC, FIV1, FIV1/FIVC%, PIF, VC, IVC, IC, ERV, FEV1/ VC%, VT, VE, Rf, ti, te, ti/t-tot, VT/ti, MVV measured, MVV calculated
Tehničke specifikacije uređaja:
• Zaslon: LCD Zaslon osjetljiv na dodir s pozadinskim osvjetljenjem
• Rezolucija: 128x65 piksela
• Napajanje: punjiva litij-ionska baterija 3.7V, 1100 mA omogućuje 30 sati mjerenja
• Prijenos podataka: USB 2.0 (Bluetooth® opcionalno)
• Akcelometar: 3 osi ± 2g, 400Hz uzorkovanje
• Dimenzije i težina: centralna jedinica: 101x48x16mm, 99g glava turbine: 46x47x24mm, 17g
• Punjač baterije (opcionalno): 100VAC - 240VAC, 50Hz-60Hz, izlaz 5VDC, 500mA, micro USB tip Bmeasured, MVV calculated
• Plug&Play
• Potpuno integriran
• Jednostavan za transport


Parametri spirometrije:
FVC, FEV1, FEV1/FVC%, FEV3, FEV3/FVC%, FEV6, FEV1/FEV6%, PEF, FEF25, FEF50, FEF75, FEF2575, FET, ELA, EVOL, FIVC, FIV1, PIF, FIV1/ FIVC%, PIF, IRV, VC, IVC, IC, ERV, FEV1/VC%, VT, VE, Rf, tI, tE, ti/tTOT, VT/ tI, MVV, PRE/POST
Tehničke karakteristike:
• Dimenzije: 49,7x142x26 mm
• Težina: 65 g
• Radi s: Višekratnom turbinom (910002) Jednokratnom turbinom (910004)
• Napajanje: USB port (5 V d.c.)
• Nazivna snaga: 0.25 W
• Nazivna ulazna struja: 50 mA max
• Promjer usnika: 30 mm
• Razina IP zaštite: IPX1
• Operativna temperatura rada: MIN +10 °C, MAX +40 °C
• Operativna razina vlage pri radu: MIN 10% RH, MAX 95% RH
Spirometrija::
• Raspon volumena: 10 L
• Raspon protoka: ±16L/s

• Senzor protoka: dvosmjerna digitalna turbina
• Točnost volumena (ATS 2019.): ±2,5% ili 50 mL
• Točnost protoka: ±5% ili 200 mL/s
• Dinamički otpor :<0,5 cm H2O/L/s
• Poluvodički senzor temperature: (0-45°C)
• Dostupni testovi: FVC, VC, IVC, MVV, PRE-POST
• Mjerni parametri: FVC, FEV1, FEV1/FVC%, FEV3, FEV3/FVC%, FEV6, FEV1/FEV6%, PEF, FEF25, FEF50, FEF75, FEF2575, FET, ELA, EVOL, FIVC, FIV1, PIF, FIV1/FIVC%, PIF, IRV, VC, IVC, IC, ERV, FEV1/ VC%, VT, VE, Rf, tI , tE , ti/tTOT, VT/tI , MVV
MiniSpir je USB spirometar za PC, dizajniran za softverska medicinska rješenja. Zahvaljujući tehnologiji Plug and Play, MiniSpir je praktično i ekonomično rješenje za visokokvalitetna mjerenja. Njegova lagana i kompaktna veličina čine ga idealnim alatom za profesionalce koji su upoznati s korištenjem računala i one koji žele pružiti točne i pravovremene usluge spirometrije s bilo kojeg mjesta . Uređaj omogućuje prikaz spirometrijskih testova u stvarnom vremenu na zaslonu računala putem namjenskog softvera MIR Spiro. Usklađenost s najnovijim smjernicama i međunarodnim standardima za spirometriju (ATS/ERS 2005 + 2019 ažuriranje; ISO 23747:2015; ISO 26782:2009), i mnogi drugi. 911006E0 | Minispir bez turbine
• Jednostavan za korištenje
• Pojednostavljena i precizna spirometrija


• Idealno za pedijatre i liječnike opće prakse
• MIR Spirobank II Smart spirometar s 1 turbinom za višekratnu upotrebu - daljinski nadzor dišnog sustava na pametan način. Spirobank II BASIC je prijenosni spirometar koji se može koristiti u samostalnom načinu rada i spojiti na računalo putem USB kabela. Jednostavan za korištenje , Spirobank II BASIC idealan je spirometar za pedijatre i liječnike opće prakse. Spirometar omogućuje prikaz spirometrijskih testova u stvarnom vremenu na zaslonu uređaja i na računalu putem softvera MIR Spiro.
Parametri spirometrije: FVC, FEV, DTPEF, PEF, FEF, FET, Vext, ELA, EVOL, FIVC, FIV, PIF, FIF, IRV, VC, IVC, IC, ERV, TV, VE, RR, MVV
Tehničke karakteristike:
• Zaslon: 160 x 80 piksela
• Ulaz: membranska tipkovnica (6 tipki)
• Povezivost: USB 2.0
• Integracija: GDT sučelje, HL7 standardno sučelje (eGA/EHR, ePA/EMR)
• Interna memorija: 10 000 testova
• Napajanje: punjiva baterija
• Vrsta baterije: Litij-ionska
• Kapacitet baterije: 1.100 mAh
• Radna temperatura: + 10 °C do + 40 °C
Spirometrija:
• Senzor protoka: Dvosmjerna digitalna turbina
• Senzor temperature: poluvodič (0 - 45 °C)
• Maksimalni volumen: 10 L
• Raspon protoka: ± 16 l/s
• Točnost volumena: ± 2,5% ili 50 ml
• Točnost protoka: ± 5% ili 200 ml/s
• Dinamički otpor:
• Parametri: FVC, FEV, DTPEF, PEF, FEF, FET, Vext, ELA, EVOL, FIVC, FIV, PIF, FIF, IRV, VC, IVC, IC, ERV, TV, VE, RR, MVV
• Test u stvarnom vremenu: FVC-Pre, FVC-Post, VC-Pre, MVV, usporedba bronhodilatatora, ekstrapolirani volumen, starost pluća
Smart One Peak Flow Metar Šifra
Šifra 91110051
Smart One® je povoljan, kućni spirometar koji nudi osnovnu razinu pregleda. Dizajniran je kao alat za samokontroluosobama s respiratornim poteškoćama i te kao jednostavan proizvod za praćenje zdravlja fizički aktivnih osoba. Bluetooth tehnologija omogućava izravno povezivanje na mobitel.
Tehničke karakteristike:
• Kategorija uređaja: Digitalni mjerač vršnog protoka zraka/FEV1
• Parametri spirometrije: FEV1, PEF
• Najviši izmjereni volumen: 10 L
• Raspon protoka: ± 960 L/minute
• Točnost volumena: ± 3%
• Točnost protoka: ± 5%
• Dinamički otpor 12 L/s: < 0.5cm H2O/L/s
• Prijenos podataka: Bluetooth® Smart (4.0 ili noviji)
• Napajanje: 2 x 1.5v AAA alkalne baterije
• Dimenzije: 109 x 49 x 21 mm
• Težina: 60.7g (s baterijom)

Spirobank II Smart spirometar s 1 turbinom za višekratnu upotrebu s opcijom oksimetrije. Multiplatformski, Spirobank II Smart nudi tri načina korištenja u jednom uređaju!
Stand Alone : za one koji žele maksimalnu slobodu kretanja bez vezivanja za svoju radnu stanicu ili vanjske uređaje.
Povezivanje s računalom putem USB kabela: za profesionalce upoznate s korištenjem računala koji traže naprednu integraciju (EMR/EHR) i dubinsku vizualizaciju podataka.
Povezivanje tableta putem Bluetootha: ili oni koji traže intuitivnu i fleksibilnu interakciju tijekom spirometrijskih postupaka.
Spirometar omogućuje prikaz spirometrijskih testova u stvarnom vremenu na zaslonu uređaja, na tabletu putem besplatne namjenske aplikacije MIR Spiro i na računalu putem softvera MIR Spiro.
Sukladnost s najnovijim smjernicama i međunarodnim standardima za spirometriju (ATS/ERS 2005 + 2019 update; ISO 23747:2015; ISO 26782:2009), oksimetriju (ISO 80601-2-61:2017) i mnoge druge.
Parametri spirometrije: FVC, FEV1, FEV1/FVC%, DTPEF, FEV 0.5, FEV0.5/FVC%, FEV0.75, FEV0.75/FVC%, FEV2, FEV2/FVC%, FEV3, FEV3/FVC%, FEV6, FEV1/ FEV6%, PEF, FEF25, FEF50, FEF75, FEF25-75, FEF75- 85%, FET, Vext, ELA, EVOL, FIVC, FIV1, PIF, FIV1/FIVC%, FIF25, FIF50, FIF75, R50, PIF, IRV, VC, IVC, IC, ERV, FEV1/VC%, TV, VE, RR, tI, tE, tI/t-tot, TV/tI, MVV
Tehničke karakteristike:
• Dimenzije: 55x160x25 mm
• Težina: 140 g (baterija uključena)
• Kategorija uređaja: Dijagnostički spirometar
• Napajanje: Punjiva litij-ionska 3.7V, 1100 mAh
• Jakost struje: 1100 mAh
• Potrošnja: ~20-30 mA (tijekom testa)
• Punjač baterije: napon=5 V DC, struja=minimalno 500 mA, konektor: mikro USB B-tip u skladu s EN 60601-1
• Autonomija: 50 sati
• Povezivost: USB, Bluetooth®
• Zaslon: LCD monokromatski, 160 × 80 piksela
• Tipkovnica: Membranska tipkovnica sa 6 tipki
• Usnici: Ø 30 mm
• Vrsta električne zaštite: Unutarnje napajanje
• Sigurnosna razina za opasnost od udara: Aparat BF tipa
• Uvjeti korištenja: Uređaj je namjijenjen kontinuiranoj upotrebi.
• Primijenjene norme: Standard električne sigurnosti IEC 60601-1:2005 + A1: 2012, Elektromagnetska kompatibilnost EN 60601-1-2:2015, ISO 26782: 2009, ISO 23747: 2015, ATS/ERS: ažuriranje iz 2005., 2019
• Senzor protoka: dvosmjerna digitalna turbina
• Mjerni raspon protoka: ±16L/s
• Točnost izmjere volumena: ±2.5% or 50 mL
• Točnost izmjere protoka: ±5% or 200 mL/s
• Dinamički otpor: <0.5 cm H2O/L/s
• Senzor temperature: poluvodič (0-45°C)
911028E1 | Spirobank + 1 višekratna turbina
911029E1 | Spirobank + Oksimetar + 1 višekratna turbina
Spirolab
Šifra
911080E1
911081E1
• Kompletan
• 7’’ zaslon osjetljiv na dodir
• Ugrađeni termalni pisač

• Kalibracija se može izvršiti na uređaju
• Testovi na uređaju u stvarnom vremenu
Spirolab je kompletan stolni spirometar s opcijom oksimetrije. Opremljen zaslonom u boji osjetljivim na dodir od 7 inča i ugrađenim termalnim pisačem. Spirolab je sveobuhvatni spirometar za brzo i sveobuhvatno izvješćivanje - bez potrebe za računalom! Dugotrajna punjiva baterija i velika interna memorija čine Spirolab idealnim uređajem za ponijeti bilo gdje. Testiranje u stvarnom vremenu i pedijatrijski poticaj dostupni su na zaslonu uređaja. Kalibracija se može izvesti izravno s uređaja . Radi i u samostalnom načinu rada i spojen na računalo putem USB kabela. Sukladnost s najnovijim smjernicama i međunarodnim standardima za spirometriju (ATS/ERS 2005 + 2019 update; ISO 23747:2015; ISO 26782:2009), oksimetriju (ISO 80601-2-61:2017) i mnoge druge.
Parametri spirometrije:
FVC, FEV1, FEV1/FVC%, FEV1/PEF, FEV1/VC, FEV1/FEF0.5, DTPEF, FEV 0.5, FEV0.5/FVC, FEV0.75, FEV0.75/FVC, FEV2, FEV2/FVC, FEV3, FEV3/FVC, FEV6, FEV1/FEV6, PEF, FEF25, FEF50, FEF75, FEF2575, FEF7585, FET, Vext, ELA, EVOL, FIVC, FIV1, PIF, FIV1/FIVC, FIF25, FIF50, FIF75, R50, MVVcal, PIF, IRV, VC, EVC, IVC, IC, ERV, IRV, FEV1/VC, TV, VE, RR, ti, te, ti/t-tot, TV/ti, MVV
Tehničke karakteristike:
Tehničke specifikacije spirometra:
• Napajanje: punjiva baterija i rad na struju
• Temperaturni senzor: semikonduktor (0-45°C)
• Sonda: digitalna bidirekcijska turbina
• Raspon protoka: ±16 l/s
• Točnost volumena: ±3% ili 50ml
• Točnost protoka: ±5% ili 200ml/s
• Dinamički otpor: <0.5 cmH2O/l/s
• Povezivanje: USB 2.0, Bluetooth® 2.1
• Zaslon: 7-inčni LCD zaslon osjetljiv na dodir
• Rezolucija: 800x480
• Usnik: Ø 30 mm
• Dimenzije: 220 x 210 x 51 mm
• Težina: 1450 g (s baterijom)
Tehničke specifikacije oksimetra (opcionalno):
• Raspon SpO2: 0-99%
• Točnost SpO2: ±2% (70-99% SpO2)
• Raspon pulsa: 18-300 BPM
• Točnost pulsa: ±2BPM or 2% (veća vrijednost)
• Memorija: do 500 sati oksimetrije
• Parametri oksimetrije: %SpO2 and Pulse Rate (Min, Max, Average), Test duration, Total SpO2 Events, T90% (SpO2 time ≤89%), T89% (SpO2 time ≤88%), T40 (Bradycardia duration with Pulse Rate <40 BPM), T120 (Tachycardia duration with Pulse Rate >120 BPM).• Punjač baterije (opcionalno): 100VAC - 240VAC, 50Hz-60Hz, izlaz 5VDC, 500mA, micro USB tip Bmeasured, MVV calculated
911080E1 | Spirolab + 1 višekratna turbina
911081E1 | Spirolab + Oksimetar + 1 višekratna turbina
Spirometar Spiro Tube Professional
Šifra
02.2.4650.00
Spirotube Professional je uređaj koji se koristi za potrebe dijagnostike i nadzora plućne funkcije Pogodan je za preglede i praćenje COPD-a i astme. Uređaj se povezuje s računalom pomoću USB kabela. Kada je Spirotube Professional povezan na računalo moguće je provesti kompletno ispitivanje radi utvrđivanja dijagnoze kao i ispitivanje nakon primjene bronhodilatatora te bronhoprovokacijsko ispitivanje. Automatizirano dijagnostičko tumačenje uz glas i videozapise koji objašnjavaju upotrebu uređaja i komuniciraju rezultate. Interni softverski jezici: GB, FR, IT, DE, ES, HU uz dostupne glasovne jezike (SAD (engleski), AU, FR, IT, DE, ES, AT, HU). Spirotube Professional ima integriranu slikovnu motivaciju koja se koristi za ispitivanje djece uz mogućnost prilagodbe težine.

Parametri spirometrije: FVC, FEV1, FEV0,5, FEV3, FEV1/FVC, FEV1/FIVC, FEV3/FVC, FEV1/ FEV6, FIV1/FIVC, PEF, FET, ELA, MME2575, FEF25, FEF50, FEF75, MMEF2550 , FEV6, FIVC, FIV1, PIF, FIF25, FIF25, FIF75, EV, nulto vrijeme, EOTV05, EOTV1, PET. , POST i PRE testovi
Tehničke karakteristike:
• Preciznost: 3%
• Rezolucija: 8 ml/sek
• Raspon protoka: +- 18 L/sek
• Stopa digitalnog uzorkovanja: 100 MHz
• Dimenzije protoka: 30 mm (OD) x 150 mm
• Dimenzije uređaja: 27 x 60 x 150 mm
• Komunikacija: USB ili serijski
Spirometar Contec SP-10 BT
Šifra
02.2.5638.00
Spirometar SP-10BT je prijenosni ručni uređaj za provjeru stanja pluća, s infracrvenim modulom za mjerenje relativnih parametara, te je namijenjen za korištenje u bolnicama i klinikama te kao rutinski kućni test.

Parametri spirometrije: FVC, FEV1, FEV1/FVC, PEF, FEF25, FEF50, FEF75, FEF2575
Tehničke karakteristike:
• Dimenzija: 97mm(D)× 89mm(Š)×36mm(V)
• Težina: 150g
• Način prikaza: 1,8’’ LCD u boji
• Razlučivost zaslona: 160*128
• Raspon volumena: 0~10L
• Preciznost volumena: ±3% ili 0,05L (što god je veće)
• Raspon protoka: 1 L/S ~16L/S
• Preciznost protoka: ±10% ili ±0,3L/s (što god je veće)
• Radna struja: 60 mA
• Napajanje: DC3.7V punjiva litijska baterija
• Sigurnosna klasifikacija: oprema s internim napajanjem, primijenjeni dio tipa BF
Višekratna turbina za MIR spirometre
Šifra 910002
Koristi se s plastičnim ili papirnatim usnikom. Višekratna turbina s metalnom mrežicom.
Tehničke karakteristike:
• Vanjski promjer: 33,3 mm
• Unutarnji promjer: 30,5 mm
• Dužina: 41,5 mm
• Težina: 20,29 g


Jednokratna turbina za MIR spirometre
Šifra 910004
Flowmir jednokratna turbina s kartonskim usnikom za MIR spirometre, 60 kom.
Tehničke karakteristike:
• Vanjski promjer: 33,3 mm
• Unutarnji promjer: 30,5 mm
• Dužina: 41,5 mm
• Težina: 20,29 g


Mini-Wright profesionalni mjerač vršnog protoka zraka
Šifra
CC-3103387
CC-3104710


Koristi za mjerenje vršnog protoka zraka te na taj način pomaže pacijentima u kontroli astme.
Tehničke karakteristike:
• Koristi se profesionalnopraćenje astme u bolnicama i klinikama
• Svaki uređaj je zasebno kalibriran kako bi se osigurala potpuna preciznost
• Lako čitljiva EU skala
• Jednostavan za čišćenje
CC-3103387 | za odrasle:
• Dimenzije:157 x 44mm (bez usnika); 210 x 44mm (s usnikom)
• Težina: 76g (s usnikom)
• Raspon mjerenja: 60 - 880 L/min
• Preciznost: ±10% or 10 L/min
• Ponovljivost: < 5 L/min
CC-3104710 | za djecu:
• Dimenzije:157 x 44mm (bez usnika); 210 x 44mm (s usnikom)
• Težina: 76g (s usnikom)
• Raspon mjerenja: 30 - 400 L/min
• Preciznost: ±10% or 10 L/min
• Ponovljivost: < 5 L/min
Papirnati usnik za spirometre
Šifra 910300_B
02.2.2431.00


Jednokratni papirnati usnik promjera 30 mm. Pakiranje od 100 komada.
910300_B | Papirnati usnik za spirometre MIR 02.2.2431.00 | Papirnati usnik za spirometre Thor
Jednokratni antibakterijski filteri za MIR spirometre

Plastična kopča za nos za MIR spirometre

Plastična kopča za nos. Preporučeno prema ATS smjernicama
AirZone kućni, džepni mjerač vršnog protoka zraka
Šifra
CC-3130160

AirZone je džepni mjerač vršnog protoka zraka s jednakom preciznošću kao i Mini-Wright Standard mjerač. Dodana prednost je sustav postavljanja zona što omogućava sigurno i precizno mjerenje u udobnosti vlastitog doma.
Tehničke karakteristike:
• Lagan i prijenosan džepni mjerač vršnog protoka zraka
• Svaki uređaj je zasebno kalibriran kako bi se osigurala potpuna preciznost
• Pogodan za djecu i odrasle
• U skladu s NAEP smjernicama
• Lako čitljiva EU skala
• Sustav postavljanja zona za lakšu samoprocjenu
• Drška za lakše rukovanje uređajem
• Jednostavan za čišćenje
• Mjerno područje između 60 - 800 l/min

Mjerač vršnog protoka zraka Rossmax
Šifra
PF120A
PF120C


Kompaktan, lagan i prijenosan mjerač vršnog protoka zraka, s ugrađenim fleksivilnim sustavom upravljanja u tri zone. Mjerači imaju veoma čitljive znamenke te jamče preciznost, uz mogućnost ponovnog mjerenja kad god i gdje god je potrebno. Prikladni za uporabu s jednokratnim nastavcima za usta te se mogu prati. Mjerači su sukladni s odredbom EN ISO 23747 : 2009, te imaju CE odobrenje.
PF120A | za odrasle
PF120C | za djecu
Mjerač vršnog protoka zraka
02.2.5639.00

Prikladan za praćenje KOPB-a, astme i kroničnog bronhitisa u bolnici i kod kuće. Povezivanje USB kablom na računalo. Mjerni parametri: FEV1, PEF. Volumen: 0.01l ~ 9.99l. Brzina protoka: 50 ~ 900l/min. Zaslon: 1.8˝LCD zaslon. Memorija: 30 mjerenja. Težina: 120 g. Dimenzije: 126x54x28 mm. Osnovni pribor: usnik, turbina, korisnički priručnik, USB kabel.
Aparat za vježbe disanja Kyara
Jednostavan i praktičan aparat koji pomaže pacijentu pri oporavku nakon operacije pluća i vraćanju normalnih respiratornih funkcija te kod vježba disanja za sve dobne skupine. Aparat sadrži tri prozirne komore od koji svaka prikazuje vrijednost udisaja po sekundi: 600, 900 i 1200 cc. Komore, kuglice i cijev s usnikom su izrađene od netoksičnog polipropilena.

Apnea alarm za bebe i djecu
02.7.4183.00
02.7.3856.00
02.7.3374.00

Uređaj za praćenje disanja djeteta (APNEA alarm). Dostupan u varijanti s 1, 2 i 3 senzora. Poseban softver prati gibanja povezana s disanjem, a alarm će se oglasiti ako disanje nije detektirano više od 20 sekundi, ako su detektirana svega 3 udisaja unutar 20 sekundi ili ako disanje postane vrlo plitko unutar 30 sekundi.
Aero spacer s maskom | komora za raspršivanje lijeka Rossmax
Šifra
AS175S
AS175M
AS175L
Tehničke karakteristike:

• Visokoučinkovit jednosmjerni ventil za lakšu inhalaciju
• Univerzalni donji dio, može se koristiti za većinu propisanih komora za raspršivanje lijeka
• Antistatička komora pospješuje unos inhalacijskog spreja smanjujući prianjanje lijeka na stijenku komore.
• Mekana i savitljiva silikonska maska je ugodna na dodir i ima pouzdanu izolaciju
• Prijenosan, lagan za nošenje
• Kapica za usni dio ga štiti od prljavštine i drugih čestica kada se uređaj ne koristi
• Ovaj uređaj ne sadrži lateks i BPA
• Zapremina komore: 175 ml
AS175S | veličina S
AS175M | veličina M
AS175L | veličina L
Aparat za vježbe disanja
Šifra
02.2.3772.00

Jednostavan i praktičan aparat koji pomaže pacijentu pri oporavku nakon operacije pluća i vraćanju normalnih respiratornih funkcija te kod vježba disanja za sve dobne skupine. Aparat se koristi i preventivno kako bi se vježbanjem poboljšao kapacitet pluća posebice u osoba koje su sklone bolestima respiratornog sustava a preporuka je da ga koriste i pušači.

Šifra
ACCUNIQ BC300
Prijenosan analizator od samo 10 kg s mogućnošću sklapanja. Upravljanje podacima preko ACCUNIQ Manager-a. 7 inčni LCD zaslon u boji. Raspon frekvencija: 5, 20, 250 kHz. Mjerenje rezultata već u 3 do 5 minuta! Odabir torbe: tkanina (815x215x410 mm; 1 kg) ili plastika (866x295x567mm; 6 kg). Opcionalan ispis rezultata za novorođenčad.
Tehničke karakteristike:
• Model: ACCUNIQ BC300
• Metoda mjerenja: Tetra-polar elektrode - korištenje 8 elektroda osjetljivih na dodir
• Frekvencijski raspon mjerenja: 5, 50, 250 kHz
• Područje mjerenja: Cijelo tijelo i njegovi segmenti (ruke, noge, trup)
• Potrošnja: 60VA
• Mjerna struja: cca. 280mA
• Zaslon: 7 inčni kolor LCD ekran
• Unos podataka putem: Tipkovnice ili povezanog računala
• Prijenos: USB Port
• Isprint: USB port za printer proizvođača, termalni printer (opcija)
• Dimenzije: Glavna jedinica: 400 X 735 X 890 mm (š x d x v)
• Težina: cca.10 kg (glavna jedinica)
• Raspon mjerenja: 100~950Ω
• Vrijeme mjerenja: Unutar 60 sekundi
• Raspon mjerenja visine: 50~220cm
• Raspon mjerenja težine: 10~250kg
• Uvjeti rada: Ambijetalna temperatura +5 do +40°C, Relativna vlaga 15 do 93% (ne kondenzirajuća)
• Uvjeti skladištenja: Ambijetalna temperatura -25 do +70°C, Relativna vlaga niža od 93% (ne kondenzirajuća)
Šifra
ACCUNIQ BC380
Ergonomski dizajn koji omogućava korisniku prilagođavanje visine i dimenzije nožnog postolja.
Jednostavno sučelje i lako za korištenje, napredna korisnička podrška kroz program ACCUNIQ Remote Support, QR kod na ispisu rezultata, upravljanje podacima preko ACCUNIQ Data
Managera. 7 inčni LCD zaslon u boji osjetljiv na dodir. Raspon frekvencija: 5, 20, 250 kHz. Opcionalno Wi-Fi i Bluethooth.


Tehničke karakteristike:
• Model: ACCUNIQ BC380
• Metoda mjerenja: Tetrapolar elektrode - korištenje 8 elektroda osjetljivih na dodir
• Frekvencijski raspon mjerenja: 5, 50, 250 kHz
• Područje mjerenja: Cijelo tijelo i njegovi segmenti (ruke, noge, trup)
• Potrošnja: 60VA
• Mjerna struja: cca. 180μA ± 15
• Zaslon: 7 inčni kolor LCD ekran osjetljiv na dodir
• Unos podataka putem: Ekrana osjetljivog na dodir, tipkovnice
• Prijenos: 5 USB Portova, 2 RS232C portova, Wi-fi, Bluetooth (opcija)
• Isprint: USB port za printer proizvođača, termalni printer (opcija)
• Dimenzije: Glavna jedinica: 641x436x1029 mm (š x d x v)
• Težina: cca. 18 kg (glavna jedinica)
• Raspon mjerenja: 100~950Ω
• Vrijeme mjerenja: Unutar 30 sekundi
• Raspon mjerenja visine: 50~220cm
• Raspon mjerenja težine: 10~250kg
• Uvjeti rada: Ambijetalna temperatura +5 do +40°C, Relativna vlaga 15 do 93% (ne kondenzirajuća)
• Uvjeti skladištenja: Ambijetalna temperatura -25 do +70°C, Relativna vlaga niža od 93% (ne kondenzirajuća)
• USB pohrana podataka: pohrana i prizivanje svih izmjerenih podataka
• QR kod: skenirajte QR kod na zaslonu ili ispisanom listu papira
s rezultatima i pregledajte podatke na računalu
• Vanjska podrška: tehnička podrška preko računala (ACCUNIQ REMOTE SUPPORT)
Šifra
SECA-mBCA555
Od 1840. godine razvijamo i proizvodimo precizne mjerne sustave i vage najviše kvalitete. Danas je seca globalni tržišni lider u području medicinskih mjernih sustava i vaga. Mjerila se postavljaju kada se ovo iskustvo i strast za preciznošću susreću s analizom tijela. Rezultat je seca Medical Body Composition Analyzer ili skraćeno seca mBCA. Valjani i precizni podaci koji se mogu koristiti u medicinskom polju. Izuzetno kratko vrijeme analize. Jednostavno korištenje. Pouzdan i ekonomičan. Radite još učinkovitije, preciznije, brže i ponudite svojim pacijentima više - počevši od sada.
seca mBCA 555 – nova generacija analize sastava tijela
Visoka kvaliteta seca mBCA 555 zajamčena je dugogodišnjim iskustvom u istraživačkim partnerstvima i suradnji s medicinskim stručnjacima. Nudi studijski potvrđenu preciznost, napredni softver temeljen na oblaku (dodatna opcija) i ultrazvučno mjerenje duljine (dodatna opcija). Njegova poboljšana grafička analiza pruža točnu i sveobuhvatnu sliku sastava tijela u nekoliko sekundi i čini analizu bioimpedancije još vrijednijom podrškom za terapiju i dijagnozu.
Brzo i jednostavno za korištenje
Medicinski odobrena klasa III seca mBCA 555 ima kapacitet težine od 300 kg. Koristeći analizu bioelektrične impedancije u 8 točaka s mjernom strujom od 100 μA, uređaj daje rezultate za samo 24 sekunde.
Razvijen u suradnji s medicinskim korisnicima
Seca mBCA 555 je BIA rješenje za iznimno precizno i korisniku jednostavno određivanje sastava tijela. Njegova jedinstvena validacija u odnosu na MRI cijelog tijela (masa skeletnih mišića) i 4C model (masa masnog tkiva) osigurava pouzdane i medicinski relevantne rezultate. Softver temeljen na oblaku preuzima sve administrativne zadatke umjesto vas, omogućujući tako potpuni fokus na vaše pacijente. Rukohvat s fiksnim položajem držanja jamči ponovljivost mjernih uvjeta.


Tehničke karakteristike:
• Medicinski odobrena klasa III

• Analiza bioelektrične impedancije u 8 točaka (BIA)
• Rezultati mjerenja za samo 24 sekunde
• Mjerna struja od 100μA
• Jedinstvena točnost kroz MRI validaciju cijelog tijela (masa skeletnih mišića) i 4C model (masa masti)
• Rukohvat s fiksnim položajem ručke: Mjerenja su ponovljiva i pouzdana
• Validacijske studije grupirane su i objavljene u European Journal of Clinical Nutrition 2013/2017, među ostalim
• Precizno i beskontaktno mjerenje visine u nekoliko sekundi pomoću najnovije ultrazvučne tehnologije
• Softver temeljen na oblaku s lako razumljivom grafikom jamči potpunu sliku sastava tijela

Oznaka razreda točnosti prvi je pokazatelj točnosti vage. Postoje 4 različita stupnja preciznosti, odnosno »klase« mjernih instrumenata. Klasa I i II se dodjeljuju vrlo preciznim mjernim instrumentima koji nisu česta pojava među svakodnevnim medicinskim proizvodima. Klasa III se dodjeljuje vagama u općoj trgovinskoj uporabi (odnosno, u ovom slučaju, kod medicinskih vaga), dok je klasa IV rezervirana za vage slabije razine preciznosti (u slučajevima gdje je to dozvoljeno). Maksimalno dozvoljeno odstupanje vage ovisi o dodijeljenoj klasi. Svi mjerni instrumenti s markicom Klase III, ovjereni od strane Državnog Zavoda za Mjeriteljstvo, pogodni su za korištenje u medicinskim ustanovama. Ostali uređaji, bez ovjerene markice Klase III namijenjeni su za kućnu uporabu, obrazovne ustanove (škole i vrtiće) i slično. Moguće je koristiti vagu višeg razreda točnosti nego što se zahtjeva.
Mehanička stupna vaga Seca 700 + visinomjer Seca 220
Mehanička vaga Seca-700 s kliznim utezima je nadograđena teleskopskim visinomjerom Seca-220. Na taj način se štedi na vremenu i moguće je u jednom mjerenju precizno utvrditi težinu i visinu pacijenta. Teleskopski visinomjer za montažu na Seca stupne vage. Lako čitanje rezultata, skala je otisnuta s vanjske strane visinomjera i rezultat je naznačen crvenom oznakom. Za izradu je korišten aluminij što visinomjer čini iznimno izdržljivim. Otporan je na grebanje. Mjerni raspon: 60 - 220 cm. Gradacija 1 mm.
Vaga Seca 700
Tehničke karakteristike:
• Mjerna jedinica: kg, lbs ili kg/lbs
• Kapacitet: 220 kg
• Gradacija: 50 g / 100 g
• Dimenzije: 520x1556x520 mm
• Masa proizvoda: 16,2 kg
• CE 0123

• Funkcije: transportni kotačići, funkcija resetiranja na nulu
Visinomjer Seca 220
Tehničke karakteristike:
• Raspon mjerenja u cm: 60 - 200 cm
• Gradacija: 1 mm
• Dimenzije (Š x V x D): 55 x 1480 x 286 mm
• Težina: 696 g,
• CE 0123
Mehanička stupna vaga Seca 756 [Klasa IIII] s BMI zaslonom + visinomjer Seca 224
Vaga Seca 756
Tehničke karakteristike:
• Klasa IV
Mehanička vaga s velikom kazaljkom i automatskim prikazom BMI raspona. Kada pacijent stane na vagu, prikazuje se ploča s BMI indeksom u kontrastnim bojama na velikom prikazu s kazaljkom. Nakon očitanja mase, iznimno je lako odrediti BMI. Vaga je dostupna s mjernom letvicom.
• kapacitet: 160 kg
• gradacija: 500g
• dimenzije: 360 x 1000 x 628 mm
• težina: 18,5 kg
• CE 0109, 0123
• Funkcije: transportni kotačići, funkcija resetiranja na nulu
Mehanička stupna vaga Seca 711 [Klasa III] + visinomjer Seca 220
Seca-711 je mehanička vaga s kliznim utezima, gradacije 100 grama i kapaciteta do 220 kilograma. Vaga je opremljena integriranim visinomjerom Seca-220. Na taj način se štedi na vremenu i moguće je u jednom mjerenju precizno utvrditi težinu i visinu pacijenta. Visinomjer je mjernog područja u rasponu od 60 do 200 centimetara, gradacije od 1 milimetra. Vaga posjeduje veliku, nisku platformu te je opremljena kotačima poradi lakšeg transporta i premještanja.
Vaga Seca 711
Tehničke karakteristike:
• Klasa III
• Mjerna jedinica: kg, lbs ili kg/lbs
• Kapacitet: 220 kg
• Gradacija: 50 g / 100 g
• Dimenzije: 520x1556x520 mm
• Masa proizvoda: 21,7 kg
• CE 0109, 0123

• Funkcije: transportni kotačići, funkcija resetiranja na nulu
Visinomjer Seca 220
Tehničke karakteristike:
• Raspon mjerenja u cm: 60 - 200 cm
• Gradacija: 1 mm
• Dimenzije (Š x V x D): 55 x 1480 x 286 mm
• Težina: 696 g,
• CE 0123
Visinomjer Seca 224
Tehničke karakteristike:
• Raspon mjerenja u cm: 60 - 200 cm
• Gradacija: 1 mm
• Dimenzije (Š x V x D): 55 x 1480 x 286 mm
• Težina: 696 g
• CE 0123


Digitaln a stupna vaga Seca 799 [Klasa III]
Šifra Opis
SECA-799 bez visinomjera
SECA-799+SECA-220 + visinomjer Seca 220
Digitalna baterijska stupna vaga idealna za svakodnevnu uporabu u zdravstvenim ustanovama. Vrlo mala potrošnja energije čini ju povoljnom i isplativom investicijom. Vaga je opremljena kotačićima za transport pa ju je jednostavno premještati. Sadrži nekoliko naprednih funkcija (TARA, HOLD, BMI) za raznovrsnu namjenu. Zaslon sadrži tipku »BMI« koja u trenu isčitava indeks tjelesne mase (BMI). BMI indeks omogućuje procjenu nutritivnog stanja pacijenta. Protuklizna podloga na gazištu osigurava sigurno korištenje vage. Napajanje na baterije. Kapacitet: do 200 kg, gradacija po 100 g < 150 kg <200 g.
Tehničke karakteristike:
• Klasa III
• Kapacitet: 200 kg
• Gradacija (g): 100 g < 150 kg > 200 g
• Napajanje: baterija (adapter kao opcija)
• Dimenzije (ŠxVxD): 294 x 831 x 417 mm
• Dimenzije postolja (ŠxVxD): 272 x 75 x 280 mm
• Težina: 6,3 kg
• Funkcije: TARE, HOLD, BMI, automatsko gašenje
Visinomjer Seca 220
Tehničke karakteristike:
• Raspon mjerenja u cm: 60 - 200 cm
• Gradacija: 1 mm
• Dimenzije (Š x V x D): 55 x 1480 x 286 mm
• Težina: 696 g,
• CE 0123


Digitalna stupna vaga Seca 704 s [Klasa III] s integriranim visinomjerom
Šifra
SECA-704s
Seca 704 s s integriranim visinomjerom cjelovita je mjerna stanica koja može izmjeriti i težinu i visinu u samo jednom koraku koji štedi vrijeme. Integrirani visinomjer s podjelom od 1 mm i rasponom mjerenja do 230 cm. Precizna, iznimno robusna seca tehnologija vage do 300 kg
Tehničke karakteristike:
• Klasa III
• Kapacitet: 300 kg
• Gradacija: 50 g / 100 g
• Napajanje: Baterija, strujni adapter
• Težina: 17,6 kg
• Funkcije: PRINT, TARE, Auto-clear, Pre-TARE, Funkcija majka/dijete, HOLD, Auto-HOLD, BMI, Automatsko isključivanje, SEND, Damping

Bežična mjerna stanica za visinu i težinu Seca 285 [Klasa III] s printerom
SECA-285DP
Iznimno brz automatski ispis težine, visine i BMI/BFR na zaslonu. Visoki kapacitet vaganja od 300 kg Granič nik za pete i čvrsti graničnik za glavu s integriranom se ca Frankfurt linijom osiguravaju točnije mjerenje. Mjerna stanica ima dva zaslona; jedan za direktno očitanje visi ne s graničnika glave i drugi multifunkcionalni zaslon na dodir za istovremeno očitanje visine, težine i BMI-a. Vaga pokazuje i najmanje pomake u težini zbog svoje 50 gram ske točnosti. Veliki izbor dodatnih funkcija; funkcija maj ka-dijete mogućava vaganje djeteta u naručju. Pomoću seca 360° bežićne tehnologije, seca 285 bežićno pre nosi rezultate na seca 360° bežićni printer
Tehničke karakteristike:
• Klasa III
• Kapacitet: 300 kg
• Gradacija: 50 g / 100 g
• Mjerni opseg visinomjera: 30-220 cm
• Dimenzije: 434x2394x466 mm
• Težina: 16 kg

• Funkcije: PRINT, Zaštita od preopterećenja, Auto-PRINT, Mjerna šipka, Transportni držači, TARE, Auto-clear, Autom. Prebacivanje raspona vaganja, Brisanje, Unos podataka o pacijentu, BFR (stopa tjelesne masti), PreTARE, Funkcija majka/dijete, HOLD, Auto-HOLD, BMI, Auto-BMI, Kalibracija, Autom. Kalibracija, Automatsko isključivanje, Bežično sučelje, SEND, RESET, Zvučni signali se mogu aktivirati, Pozadinsko osvjetljenje, cm/inch-prebacivanje, Prigušivanje, Korisnički definirana nulta postavka, Auto-SEND
• CE 0109, 0123

Vaga za patologiju Seca 856
Šifra
Precizna vaga WLC 6/B1
Šifra
Vaga za mjerenje mase organa zaštićena je od prodora tjelesnih fluida u nju, te zadovoljava neophodne i rigorozne higijenske standarde. Pomoću pre-TARE funkcije moguće je precizno odrediti masu vaganih materijala.
Tehničke karakteristike:
• Kapacitet: 5 kg.
• Gradacija: 1 g < 3 kg > 2 g,
• Dimenzije: 265 x 53 x 265 mm.
• Masa proizvoda: 1,9 kg.

• Funkcije: TARE, Pre-TARE, HOLD, izmjena mjerne jedinice, automatsko gašenje
Digitalna vaga stolac za teško pokretne pacijente Seca 956 [Klasa III]
SECA-856 Šifra
SECA-956
Kapacitetom 200 kg i stupnjevanjem od 100 grama, seca 956 ispunjava sve osnovne medicinske standarde. Dodatno su tipične seca prednosti kao preklopni naslon za ruke i noge, ergonomsko sjedalo, besprijekorno okretajući kotači s kočnicama, koji zajedno s ergonomski oblikovanom drškom omogućuju veoma lako upravljanje kolicima.
02.6.1781.00

LCD zaslon s pozadinskim osvjetljenjem Raspon mjerenja: 600 g. Gradacija: 0,01 g. TARA raspon: -600 g. Ponovljivost: 0,01 g. Linearnost: ± 0,01 g. Dimenzije mjerne površine: 125×145 mm. Napajanje: 230 V.
Precizna vaga
Šifra
PS 2100 R2

Mjerno područje do 2100 g, e= 0,01g / t=2100g. Automatska interna kalibracija. napajanje 230V / 11V AC i 6×AA. Dimenzija plohe za vaganje 195 x 195 mm.
Digitalna vaga stolac za teško pokretne pacijente, spremna za BIS (bolničko informatički sustav) Seca 959 [Klasa III]
SECA-959
Tehničke karakteristike:

• Klasa III
• Mjerni raspon: 200 kg
• Točnost: 100 g
• Funkcije: TARA, HOLD
• Dimenzije: 563 x 897 x 956 mm
• Neto težina: 22,4 kg
• CE 0109, 0123

Kapacitetom 300 kg i točnosti od čak 50 grama, seca 959 zadovoljava sve potrebe od pedijatrije do domova za starije teško pokretne osobe. Čelični okvir i ugodno sjedalo s preklopnim naslonima za ruke i izvlačnim osloncima za stopala. Kočnice na stražnjim kotačima omogućavaju siguran pristup i silazak pacijentima s vage.

Tehničke karakteristike:
• Klasa III
• Mjerni raspon: 300 kg
• Točnost: 100 g
• Funkcije: TARA, HOLD
• Dimenzije: 563 x 897 x 978 mm
• Neto težina: 22,4 kg
• CE 0109, 0123

Samostojeći visinomjer za djecu i odrasle Seca 213
visinomjer, Soehnle
Prijenosni, sklopivi visinomjer male težine posebno prikla dan za terensku upotrebu. Jednostavno rastavljanje i skla panje. Fiksatori i veliko postolje osiguravaju pravilan položaj visinomjera i stabilnost bez dodatnih konektora i montaže na zid. Lako očitanje rezultata za vrijeme mjerenja pomoću dva velika prozora crvene boje. Vrijednosti su otisnute s obje boč ne strane visinomjera. Raspon mjerenja do 205 cm.
Tehničke karakteristike:
• Mjerno područje: 20 - 205 cm
• Graduacija 1 mm
• Dimenzije: 337x2130x590 mm
• Dimenzije - sklopive: 337x177x624 mm
• Masa: 2.4 kg
Teleskopski visinomjer Seca 220

Teleskopski visinomjer s lako čitljivom skalom za očitanje re zultata mjerenja - mjerna skala nalazi se na bočnoj strani visi nomjera s oznakama u boji. Visinomjer je napravljen od alu minija što ga čini posebno izdržljivim a gradacija je naprav ljena u tehnici sitotiska visoke kvalitete što ga čini otpornim na abraziju.
Tehničke karakteristike:
• Raspon mjerenja u cm: 60 - 200 cm
• Gradacija: 1 mm
• Mjere (Š x V x D): 55 x 1480 x 286 mm
• Neto težina: 696 g
Mehanički visinomjer za odrasle Seca 222
Šifra
Ultrazvučni visinomjer posebno je dizajniran za odjele pedijatrije i za bolnice. Jednostavan i lijep dizajn, ugrađena automatska elektronička libela. Time je omogućeno slobodno mjerenje u prostoru i osigurana iznimno velika preciznost i brzina mjerenja u svako doba. Postupak mjerenja nije zahtjevan zato što je uređaj opremljen zvučnim signalom i funkcijom automatske pohrane rezultata mjerenja. Napajanje: 2 baterije, 1,5 V AA alkalne. Ultrazvučna tehnologija mjerenja. Senzor nagiba omogućuje korekciju ako je mjerni instrument izvan horizontalne ravnine, zbog čega se pojavljuje poruka o pogrešci.
Visinomjer, Soehnle

Tehničke karakteristike:
• Raspon mjerenja: 105-210 cm
• Podjeljak: 0,5 cm
• Dimenzije: 50 × 1,175 × 22 cm
• Težina: 0,8 kg
• Može se postaviti na zid
• Sklopiv
Ultrazvučni visionomjer


Mehanički visinomjer s velikim rasponom mjerenja - do 230 cm, namijenjen za mjerenje iznimno visokih pacijenata. Ko risti se u endokrinologiji i dijabetologiji. Visinomjer sadrži i graničnik za pete što omoćava idealno mjerenje u 3 pozicije Dizajniran za montažu na zid. Lako čitanje rezultata, čak i kod visokih pacijenata zahvaljujući širokom visinomjeru s brojevi ma otisnutim u visokoj kvaliteti. Visinomjer je izrađen od alu minija, izdržljiv je i otporan na ogrebotine.
Tehničke karakteristike:
• Mjerne jedinice: cm / inch
• Masa proizvoda: 1,1 kg
• Mjerni raspon: 6 - 230 cm
• Dimenzije: 308x2320x286 mm
• Gradacija: 1 mm
• CE 0123
• Pokazivač otporan na grebanje.
• Montaža na zid.

Ultrazvučni visinomjer za ACCUNIQ BC510 / BC380 /BC360 / BC300. Ultrazvučni visinomjer automatski, brzo i precizno mjeri visinu zahvaljujući umjetnoj inteligenciji i tehnologiji ultrazvučnog mjerenja.

Visinomjer za djecu i odrasle Seca 206
Visinomjer s namatajućim mehanizmom koji štedi prostor. Jednostavno pričvršćivanje na zid. Mjerenje visine do 220 cm.
Tehničke karakteristike:
• Mjerna jedinica: cm
• Masa proizvoda: 0,2 kg
• Mjerni raspon: 0 - 220 cm
• Dimenzije: 125x125x173 mm
• Gradacija: 1 mm
• Pokazivač otporan na grebanje
• Montaža na zid

Digitalna vaga za bebe i djecu Seca 384 [Klasa III]

Digitalna vaga kapaciteta do 20 kg, graduacije 10 g <10 kg >20 g. Robusna patronažna vaga s dvostrukom funkcijom. Vaga s montiranim koritom služi zasigurno i udobno vaganje beba. Jednostavnim pritiskom na gumb, korito se može odvojiti od postolja. Postolje potom služi za vaganje djece (do 20 kg) u stajaćem položaju. Prijenosna vaga ima napajanje na baterije. S jednim setom baterija moguće je napraviti 20.000 mjerenja Može se nadograditi dužinomjerom Seca-417 te za prijenos vage odgovaraju torbe Seca-413 i Seca-414.
Tehničke karakteristike:
• Klasa: III
• Mjerne jedinice: kg
• Kapacitet: 20 kg
• Gradacija: 10 g < 20 kg > 20 g
• Napajanje: baterija
• Dimenzije: 552x165x362 mm
• Masa proizvoda: 2.8 kg
• Funkcije: TARE, automatsko mjerenje, automatsko gašenje, BMIF, HOLD
• CE 0109, 0123
Elektronska dječja vaga Seca 336O [Klasa III] Šifra
Elektronska dječja vaga

Seca model 3360 inovativne je tehnologije i dizajna koji štedi prostor (Integrirana ručka za prijenos i vješanje vage). Ova lagana i prenosiva vaga pruža brze i precizne rezultate mjerenja zbog automatskog sustava prigušenja micanja bebe. Rezultati se prikazuju na velikom, i preglednom LCD zaslonu.
Tehničke karakteristike:
• Klasa: III
• Kapacitet: 20 kg
• Graduacija: 5 g < 10 kg > 10 g
• Funkcije: TARE, BMIF ( kontrola unosa mlijeka ), HOLD, Auto-HOLD, automatsko prebacivanje u precizniji način rada, automatski sustav prigušivanja micanja bebe, automatsko gašenje
• Dimenzije: 650 x 110 x 308 mm
• Napajanje: baterijsko, strujni punjač uz nadoplatu
• Može se proširiti dužinomjerom SECA 232_n, analogni, montaža na vagu
• CE 0109, 0123
Digitalna vaga za bebe s velikim koritom za vaganje Seca 376 [Klasa III]

Digitalna vaga sa seca 360° bežičnom tehnologijom. Sigurna i udobna s najvišom seca preciznošću od samo 5 g. Idealna za neonatologiju i pedijatriju. Prednost vage je “breast milk intake” funkcija, koja prikazuje koliko je beba pojela mlijeka, kao i inovativno, duboko korito. Duži pritisak na tipku TARE, možete izračunati težinu bebe unatoč pelenama ili ručniku. HOLD funkcija Vam omogućava memoriranje težine, tako da se bez brige možete posvetiti bebi.
Tehničke karakteristike:
• Klasa: III
• Mjerne jedinice: kg
• Kapacitet: 20 kg
• Gradacija: 5 g < 7,5 kg > 10 g
• Napajanje: baterije ili strujni kabel
• Dimenzije: 620x190x358 mm
• Masa proizvoda: 3,7 kg
• Funkcije: Auto-SEND, Damping, Zvučni signali se mogu aktivirati, RESET, SEND, Bežično sučelje, Automatsko isključivanje, Auto-HOLD, HOLD, BMIF, Autom. Prebacivanje raspona vaganja, automatsko brisanje, TARE, zaštita od preopterećenja
• CE 0109, 0123
Digitalna vaga za bebe SECA 336i [Klasa III] spremna za BIS (bolničko informatički sustav) s Wi-Fi funkcijom
Elektronska dječja vaga
Seca model 336i tehnološki je naprednija inačica SECA-3360 vage. Inovativna tehnologija spremna za BIS (bolničko informatički sustav) i dizajn prilagođen intuitivnoj upotrebi štedi prostor uz pomoć Integrirane ručke za prijenos i vješanje vage. Ova lagana i prenosiva vaga pruža brze i precizne rezultate mjerenja zbog automatskog sustava prigušenja micanja bebe. Rezultati se prikazuju na velikom, i preglednom LCD zaslonu. SECA-336i opremljena je s USB ulazom za povezivanje bar koda čitača kojim se podaci pacijenata bežično prenose u informacijski sustav čime se omogućava jednostavnost rada i smanjuje se mogućnost pogreške kod prijenosa podataka u sustav.
Tehničke karakteristike:
• Klasa: III
• Kapacitet: 20 kg

• Graduacija: 5 g < 10 kg > 10 g
• Funkcije: TARE, BMIF (kontrola unosa mlijeka), HOLD, Auto-HOLD, automatsko prebacivanje u precizniji način rada, automatski sustav prigušivanja micanja bebe, automatsko gašenje
• Dimenzije: 650 x 110 x 308 mm
• Napajanje: baterijsko ili uz strujni punjač (naručuje se zasebno)
• Može se proširiti dužinomjerom SECA 232_n, analogni, montaža na vagu
• CE 0109, 0123
Digitalna vaga za bebe i djecu
Šifra
SECA-834
Digitalna vaga za bebe i djecu s velikim mjernim rasponom i odvojivim koritom od postolja. Mjerni raspon: 20 kg. Preciznost: 10 g <10 kg> 20 g.
Funkcije: TARA, HOLD, BMIF, SWITCH OFF. Može se nadograditi dužinomjerom Seca-417 te za prijenos vage odgovaraju torbe Seca-413 i Seca-414. Jednostavnim pritiskom na gumb, korito se odvaja od postolja i time se dobiva čvrsta ravna vaga za mjerenje djece do 20 kg. Korito i postolje su povezani sigurnosnim mehanizmom što znači da se u tom obliku mogu sigurno prenositi. Korito je blago zaobljeno, drži dijete na mjestu i omogućava sigurno mjerenje. Breast-Intake funkcija prikazuje točnu količinu mlijeka koje je dijete konzumiralo.
Tehničke karakteristike:
• Klasa: IV
• Mjerne jedinice: kg
• Kapacitet: 20 kg
• Gradacija: 10 g < 10 kg > 20 g
• Napajanje: baterije
• Dimenzije: 552 x 156 x 341 mm
• Masa proizvoda: 2.5 kg

Modularna digitalna vaga s dužinomjerom za novorođenčad i djecu Vitammy GROW
Šifra TOW016686
Vitammy GROW je modularna digitalna vaga za novorođenčad, bebe i djecu s odvojivim koritom i integriranim dužinomjerom | 100kg/10g. Modularnost Vitammy Grow elektronička vaga očituje se u mogućnosti odvajanja korita (posude za vaganje) što omogućuje sigurno i precizno vaganje novorođenčadi i beba te praćenje njihovog dnevnog napretka u težini te integrirani dužinomjer kojim možete pratiti napredak rasta svojeg djeteta.

Tehničke karakteristike:
• Napajanje: 2 x AAA, 1,5 V baterije
• Načini rada: mjerenje težine, mjerenje dužine (do 60 cm), tare funkcija, funkcija Hold, automatsko isključivanje
• Nosivost: 100 kg
• Zaslon: LED, 55 x 22 mm
• Indikatori: indikator preopterećenja, indikator slabe baterije
• Odabir jedinica mjerenja: kg/lb/oz
• Fukcije: TARE, BMIF, HOLD, Automatsko gašenje
• CE 0109, 0123
Digitalna vaga za bebe Kilö
Šifra BB125K
Pratite dobitak na težini svoje bebe od trenutka kada se iz rodilišta vratite svojem domu. Jednostavna za korištenje i izdržljiva digitalna vaga za bebe Kilö pružit će vam bezbrižnost prateći rast i težinu vaše bebe, osobito u periodu kada dojite dijete ili je djete na posebnoj prehrani ili dohrani. Ova elegantna i ergonomski dizajnirana vaga bit će izvrstan dodatk dječjoj sobi vaše bebe.
Tehničke karakteristike:

• Vrlo precizna vaga: ± 5 g/0,01 lb
• Zaslon: Veliki LCD zaslon
• Mogućnosti vage: Funkcija tariranja (nuliranje vage), Funkcija zadržavanja olakšava očitanje težine bebe kada se beba miče, Indikator slabe baterije, Automatsko isključivanje, Upozorenje o preopterećenju
• Mjerne jedinice: kg | lb | oz
• Maksimalni kapacitet: 44 lbs / 20 kg
• Napajanje: Baterija CR2023
• Dimenzije: 56 cm x 33 cm x 4,1 cm
Digitalna vaga za bebe Momert
Šifra MM6401
Kompaktna i lako prenosiva vaga male težina namijenjena mjerenju težine beba do otprilike 6 mjeseci starosti odnosno do maksimalno 20 kg težine uz preciznost od 5 g. Idelana za roditelje koje žele pratiti usporedbu težine djeteta prije i nakon hranjenja.
Tehničke karakteristike:
• Težina do koje vaga važe: 20 kg
• Preciznost prikaza: 5 g
• Prikaz izmejrene težine u: kg/lb/st

• Napajanje: CR2032 litijska baterija x 2 (uključene)
• Dimenzije vage (ŠxVxD): 35 cm x 14 cm x 55 cm
• Funkcije: automatsko isključivanje, prikaz preopterećenja, prikaz upozorenja slabe baterije, memorija izmjerene težine, funkcija prikaza razlike u težini, tare funkcija
Digitalna vaga za bebe i djecu Momert
Šifra MM6470
Dječja vaga sa plastičnom posudom koja se koristi i za bebe. Posuda za bebe se može maknuti pa se koristi i kao dječja vaga.
Tehničke karakteristike:
• Preciznost 10 g i kapacitet 20 kg.

• Funkcija razlike u težini: roditelji mogu pratiti težinu beba nakon hranjenja.
• LCD zaslon, funkcija zaključavanja težine, automatsko isključivanje.
• Tare i autohold funkcija.
• Radi na 2xCR2032 baterije (uključene).
Mehanička vaga za bebe Seca 745 [Klasa III]
Šifra SECA-745
Mehanička vaga s kliznim utezima. Kapacitet do 16 kg, gradacije 10 g. Klasičan dizajn s mehanikom visoke preciznosti dostupan na tržištu već 50 godina. Precizno određivanje težine uz pomoć potpunog resetiranja na nulu. Uz pomoć ove funkcije se može oduzeti težina mekane podloge ili pelena. Lagano zakrivljeno korito drži bebu u pravilnoj poziciji tijekom mjerenja. Za potrebe čišćenja, korito se može odvojiti. Robusna čelična konstrukcija je otporna na udarce i ima premaz koji štiti od ogrebotina što jamči dugotrajnost ove omiljene vage za mjerenje beba.
Tehničke karakteristike:
• Klasa: III
• Mjerne jedinice: kg
• Kapacitet: 16 kg
• Gradacija: 10 g
• Dimenzije: 550x180x290 mm
• Masa proizvoda: 6.4 kg
• Fukcije: reset na nulu
• CE 0109, 0123


Mehanička vaga za bebe
Šifra
02.6.1823.00
Korito se može odvojiti od postolja. Posebna zaštitna tkanina. Mjerni raspon 13 kg. Preciznost: 10 g.


Ergonomska traka za mjerenje opsega
Trake za mjerenje opsega glave beba
Ergonomska traka za mjerenje opsega s veoma čitkim i jasnim brojkama. Traka se jednostavno koristi jednom rukom pomoću povratnog mehanizma. Kompaktna i jednostavna za skladištenje.
Tehničke karakteristike:
• Mjerna jedinica: cm
• Masa proizvoda: 50g
• Mjerni raspon: 0 - 205 cm
• Dimenzije: 70x33x65 mm
• Gradacija: 1 mm
• CE 0123


Ergonomska traka s WHR kalkulatorom
Ergonomska traka za mjerenje opsega s dodatnom funkcijom za mjerenje omjera struka i bedara (WHR kalkulator), koji se koristi za brzo određivanje raspodjele masti u tijelu.
Tehničke karakteristike:
• Mjerna jedinica: cm
• Masa proizvoda: 70g
• Mjerni raspon: 0 - 205 cm
• Dimenzije: 70x28x66 mm
• Gradacija: 1 mm
• CE 0123


Traka za mjerenje izrađena od nerastezljivog teflonskog materijala s dvostrukom funkcijom mjerenja opsega glave (s prednje strane trake) te simetrije lica (sa stražnje strane). Namjenjena za mjerenje opsega glave kod beba i male djece.
Tehničke karakteristike:
• Mjerna jedinica: cm, inch
• Masa proizvoda: 60g
• Mjerni raspon: 0 - 59 cm
• Dimenzije: 25x1x663 mm
• Gradacija: 1 mm
• CE 0123


Platforma za mjerenje duljine beba
i male djece | Seca 416

Robusna i velika konstrukcija omogućuje iznimno jednostavno i brzo mjerenje u neonatologiji i pedijatriji. Precizno mjerenje (uz malu mogućnost pogreške do 2 mm) omogućuje utvrđivanje deformacija u rastu. Namjerenjena je za bebe i djecu do 2 godine starosti. Platforma je dizajnirana tako da je lagano uzdignuta te ima blago nakošene rubove kako bi se dijete postavilo u pravilnu poziciju za mjerenje. Donji dio platforme s graničnikom za noge je pomičan. Nakon određivanja dužine, graničnik za noge se zaključava u poziciji što omogućuje korisniku prvo zbrinjavanje djeteta te naknadno uzimanje mjera.Kočnica se jednostavno otpušta pritiskom na gumb.

Tehničke karakteristike:
• Mjerne jedinice: cm/ inch
• Raspon mjerenja: 33 - 100 cm
• Gradacija: 1 mm
• Dimenzije: 1103x169x402 mm
• Masa proizvoda: 3,8 kg
• Mjerenje u ležećem položaju
• CE 0123

Dužinomjer za dječje vage | Seca 417

Dužinomjer za vage Seca-834 i Seca-384 Lagani i preklopni dužinomjer prikladan za prijenos. Izrađen od visokokvalitetnih materijala s glatko oblikovanom površinom za lakše čišćenje i održavanje. Koristi se u patronaži. Mjerni raspon: 10 - 100 cm, gradacija: 1 mm.
Tehničke karakteristike:
• Mjerne jedinice: cm/ inch
• Raspon mjerenja: 10 - 100 cm
• Gradacija: 1 mm
• Dimenzije: 1110x115x333 mm
• Masa proizvoda: 1,6 kg
• Mjerenje u ležećem položaju
• CE 0123

Dužinomjer za dječje vage | Seca 232_N

Dužinomjer za dječje vage Seca 336 i, Seca 333 i i Seca 336 s jasnim očitanjem i s integriranim podesivačem za glavu i stopala. Mjerni raspon: 35 - 80 cm, gradacija: 1 mm. Rezultati mjerenja lako su čitljivi s poboljšanim oznakama u boji. Izdržljiva mjerna šipka izrađena od aluminija. Jednostavno sastavljanje kao i očitavanje zaslona: analogna mjerna šipka s integriranim pozicionerima za glavu i stopala čini seca 336 i, seca 333 i i seca 336 još učinkovitijima jer se mjerenje i vaganje sada obavljaju u jednom procesu.
Tehničke karakteristike:
• Mjerne jedinice: cm/ inch
• Raspon mjerenja: 35 - 80 cm
• Gradacija: 1 mm
• Dimenzije: 640x145x277 mm
• Masa proizvoda: 512 g
• Mjerenje u ležećem položaju
• CE 0123

Dužinomjer za dječje vage | Seca 210

Lagan dužinomjer s prijenosnom podlogom koja je periva i sklopiva. Seca-210 dužinomjer je namijenjen mjerenju beba i male djece u ležećem položaju. Mjerno područje 10 – 99 cm. Gradacija 5 mm. Jednostavan za čišćenje s komercijalno dostupnim dezinficijensima. Blag materijal prema bebinoj koži. Fiksirano uzglavlje i pomičan graničnik za noge olakšavaju korištenje. Mjerna površina se jednostavno zarola što olakšava transport i štedi prostor.
Tehničke karakteristike:
• Preciznost: osnovna (1/3)
• Težina proizvoda: 0,58 kg
• Dimenzije: 1,250 x 140 x 300 mm

• Dimenzije – sklopive: 300 x 140 x 120 mm
• Mjerne jedinice: cm/inch
• Mjerni raspon: 10-99 cm
• Gradacija: 5 mm
• Materijal otporan na toplinu
• Pokazivač otporan na grebanje
• Prenosiv dužinomjer

Dužinomjer za dječje vage Metar za mjerenje visine
Metar se može postaviti na zid,Raspon mjerenja do 200 cm.

Precizan i stabilan instrument za mjerenje dužine dojenčadi i male djece. Gradacija 1 cm.

Torba za prijenos dužinomjera Seca 417 i visinomjera Seca 213
Torba sadrži prilagodljivu na ramenicu po dužini. Izrađena je od čvrstog najlona otpor nog na vodu i prašinu. Dimen zije: 686 x 427 x 56 mm, masa proizvoda: 650 g.
Tehničke karakteristike:
• Dimenzije: 686 x 427 x 56 mm
• Masa proizvoda: 650 g
• Materijal: najlon
• Otporno na vodu i prašinu

Torba za prijenos vage Seca 877
Torba za prijenos dječje vage Seca 336O Šifra
Torba za prijenos vage Seca 384, 385, 354 i 834
Torba sadrži prilagodljivu naramenicu po dužini. Izrađena je od izdržljivog najlona otpornog na vodu i prašinu. Dimenzije: 570 x 150 x 330 mm, masa proizvoda: 900 g.
Tehničke karakteristike:
• Dimenzije: 570 x 150 x 330 mm
• Masa proizvoda: 900 g
• Materijal: najlon
• Otporno na vodu i prašinu

Torba sadrži prilagodljivu naramenicu po dužini. Izrađena je od čvrstog najlona otpornog na vodu i prašinu. Dimenzije: 330 x 380 x 70 mm, masa proizvoda: 800 g.
Tehničke karakteristike:
• Dimenzije: 686 x 427 x 56 mm
• Masa proizvoda: 650 g
• Materijal: najlon
• Otporno na vodu i prašinu.

Torba sadrži prilagodljivu naramenicu po dužini. Izrađena je od izdržljivog najlona otpornog na vodu i prašinu. Dimenzije: 630x330x110 mm, masa proi zvoda: 1,2 kg.
Tehničke karakteristike:
• Dimenzije: 630 x 330 x 110 mm
• Masa proizvoda: 1,2 kg
• Materijal: najlon
• Otporno na vodu i prašinu.


Digitalna podna vaga Seca 877 [Klasa III]
Šifra
SECA-877
Pravo rješenje ako tražite laganu vagu (samo 4,2 kg) koja je stabilna, kompaktna, jednostavna za čišćenje i opremljena funkcijom majka/dijete.
Tehničke karakteristike:
• Klasa III
• Kapacitet do 200 kg
• Gradacija 100 g< 150 kg< 200 g
• Dimenzije: 321 x 60 x 356 mm

• Neto težina: 4,2 kg
• Funkcija majka-dijete
• Napajanje putem baterija
• CE 0109, 0123
Vitammy Horizon | elektronička, analitička vaga
Šifra
TOW021414
Precizna elektronička, analitička vaga Vitammy Horizon– mjeri udio masnoće, vode, mišića, kosti, index tjelesne mase (BMI) i kalorija Može li kupaonska vaga istovremeno biti precizna, bogata funkcijama, jednostavna za uporabu, pouzdana i... jednostavno lijepa? NARAVNO DA MOŽE! Vitammy Horizon ne samo da će vam pomoći u svakodnevnom praćenju tjelesne težine i drugih parametara važnih za održavanje kondicije, nego će svojim bezvremenskim, suptilnim izgledom i snježno bijelom staklenom površinom unijeti dašak elegancije i modernosti u vaš prostor.

Za sve članove obitelji Uređaj će koristiti svi članovi obitelji – Vitammy Horizon omogućuje spremanje do 10 individualnih profila korisnika, čime omogućuje da cijela obitelj bez ograničenja koristi napredne funkcije Vitammy Horizon vage. Više od obične vage... Vitammy Horizon je i analizator tjelesne mase. Osim preciznog mjerenja težine, Vitammy Horizon nudi i naprednu analizu tjelesne mase. Zahvaljujući ugrađenim senzorima i tehnologiji BIA (Bioelektrična Impedancija), Vitammy Horizon mjeri: Postotak tjelesne masti; Mišićnu masu; Koštanu masu; Vodu u tijelu (ukupna količina vode u tijelu – TBW). Vaga također izračunava: Indeks tjelesne mase (BMI) koji ukazuje na to je li vaša tjelesna težina u normali, imate li manjak, višak ili pretilost; Bazalni metabolizam (BMR) u kilokalorijama – broj kalorija potrebnih tijelu tijekom 24 sata za održavanje osnovnih životnih funkcija.
Sadržaj seta:
• Elektronička vaga Vitammy Horizon.
• Dvije baterije AAA od 1,5 V (uključene u set).
• Upute za uporabu na poljskom jeziku i jamstveni list.
• Originalno pakiranje.

Digitalna vaga s fotonaponskom ćelijom
Šifra
PS1037
Ova je vaga jedinstvena po tome što se napaja putem solarnih ćelija što znači da ne morate više kupovati baterije niti ih bacati i time zagađivati okoliš. Mjeri težinu do 150 kilograma. Točnost mjerenja: 100 g. Gazište od kaljenog stakla debljine 6 mm.
Tehničke karakteristike:
• Mjeri težinu do 150 kilograma.
• Točnost mjerenja: 100 g.

• Gazište od kaljenog stakla debljine 6 mm što ju čini iznimno izdržljivom.
• Automatsko isključivanje.
• Decentnog dizajna, uklopit će se u svaki prostor.
Osobna digitalna vaga
Šifra
MM5874
Površina od sigurnosnog kaljenog stakla u crnoj boji s decentnim biljnim uzorkom. LED zaslon s preglednim crvenim brojkama. Vaga je opremljena funkcijom automatskog gašenja, indikatorom preopterećenosti i indikatorom slabe baterije.
Tehničke karakteristike:
• Nosivost 180 kg
• Preciznost 100 g

• LED zaslon s preglednim crvenim brojkama
Digitalne kupaonske vage s uzorkom
Šifra
MM58702
MM58703
MM58704
Tehničke karakteristike:
• Težina do koje vaga važe: 180 kg
• Preciznost prikaza: 100 g
• Prikaz izmejrene težine u: kg/lb/st
• Napajanje: CR2032 litijska baterija (uključena)
• Funkcije: LCD zaslon, površina od sigurnosnog stakla, automatsko isključivanje, prikaz preopterećenja, prikaz upozorenja slabe baterije, brzi start
MM58702 | s uzorkom leptira | plava MM58703 | crna MM58704 | bijela



Osobna digitalna vaga s velikim zaslonom
Šifra
MM5253
Digitalna kupaonska vaga s velikom platformom za vaganje i velikim zaslonom koji ima velike, lako čitljive brojke.
Tehničke karakteristike:
• Automatsko isključivanje i resetiranje
• Čvrsta i robustna izrada

• Nosivost 225 kg, preciznost 100 g
• Mjerenje u kg/lb/st
• Napišite recenz
Analogna vaga Seca 761 [Klasa III]
Mehanička osobna vaga s velikom kazaljkom za preciznije očitanje rezultata. Kapacitet do 150 kg Njemačka kvaliteta! S velikom, niskom platformom protiv klizanja i završnom obradom otpornom na ogrebotine.
Tehničke karakteristike:
• Klasa III
• Mjerne jedinice: kg
• Kapacitet: 150 kg
• Gradacija: 1 kg
• Dimenzije: 303x118x470 mm
• Masa proizvoda: 3,5 kg
• CE 0109, 0123


Analogna vaga Seca 761 [Klasa III]
Tradicionalni dizajn. Nosivost 125 kg i preciznost 1 kg.
Tehničke karakteristike:
• Mjerne jedinice: kg
• Kapacitet: 125 kg
• Gradacija: 1 kg

Osobna digitalna vaga sa 7 funkcija
Šifra
MM5876
Mjeri ukupnu težinu tijela, težinu masnog tkiva, vode, kostiju, mišićnu masu, BMI (body mass index) i dnevnu potrošnju kalorija
Tehničke karakteristike:
• Nosivost 180 kg
• Preciznost 100 g
• LCD zaslon
• Najnovija BIA tehnologija mjerenja

• Memorije za 10 korisnika
• Mod za sportaše ili normalni način rada
• Automatsko gašenje
• Indikatori preopterećenosti i slabe baterije
Osobna mehanička vaga velikog brojčanika
Analogna kupaonska vaga s velikom platformom za vaganje i velikim brojčanikom koji ima velike, lako čitljive brojke. Čvrsta i robustna izrada.
Tehničke karakteristike:
• Mjerne jedinice: kg
• Kapacitet: 200 kg
• Gradacija: 1 kg
• Dimenzije: 435×320×70 mm

Osobna mehanička vaga velikog brojčanika
Kupaonska vaga s velikom platformom za vaganje i velikim, lako čitljivim brojkama. Čvrsta i robustna izrada. Namijenjena korištenju 4 osobe - svaka osoba može svoju težinu označiti oznakom u jednoj od 4 ponuđene boje.
Tehničke karakteristike:
• Mjerne jedinice: kg
• Kapacitet: 160/200 kg
• Gradacija: 1 kg
• Dimenzije: 435×320×70 mm
MM5220 | 160 kg
MM5207 | 200 kg


Mehanički metalni kaliper
02.7.1754.00

Ovom metodom se, na 7 mjesta na tijelu, pomoću posebnog mjernog instrumenta Kaliper mjeri veličinu kožnih nabora. Nabori kože na našem tijelu predstavljaju debljinu potkožnog masnog tkiva. Nakon što smo izvršili mjerenje, putem posebne jednadžbe dobit ćemo podatak o postotku potkožnog masnog tkiva.
7 mjesta odnosno nabora na kojima se vrši mjerenje:
• abdominalni vertikalni nabor
• triceps – vertikalni nabor
• prsa – dijagonalni nabor
• midaksilarni vertikalni nabor
• subskapularni dijagonalni nabor
• suprailijakalni dijagonalni nabor
• bedro – vertikalni nabor
Mehanički metalni kaliper
02.7.5348.00
Mehanički kaliper – mjerač kožnog nabora. Plastični.

Digitalni kaliper - mjerač kožnog nabora
02.7.2602.00
Tehničke karakteristike:
• Lagan uređaj s LCD zaslonom koji se lako čita.
• Brzi rezultati mjerenja, jednostavan za upotrebu.
• Mjerne jedinice: mm/inči
• Manualno isključivanje
• Indikator slabe baterije
• Raspon mjerenja: 0-50 mm
• Podjeljak: 0,01 mm / 0,0005’
Tonometar Schiötz
02.7.1685.00
02.7.2088.00


Skoliometar
02.7.5364.00

Instrument za praćenje stupnja zakrivljenosti kralježnice . Dimenzije 17,5 × 6,7 × 2 cm
Dinamometar
02.7.5357.00
Namijenjen za kućnu uporabu, za klinike i bolnice te za profesionalne sportaše. Kapacitet: 90 kg, podjeljak: 0.1 kg. Velik, lako čitljiv zaslon na kojem je prikazan ID korisnika, dob i sila stezanja u kg. Memorija: 19 korisničkih podataka.

Goniometar – ortopedski kutomjer
02.7.0650.00


Ovo remek djelo preciznog me hanizma mjeri intraokularni tlak u skladu sa standardima prof. Schiötza. Glavni dijelovi instru menta izrađeni su od nehrđajućeg čelika. Ležaj instrumenta od ahat kamena. Set od tri utega (5,5 – 7,5 – 10 g). Specifikacija ravne skale 5. Dolazi u crnoj deluxe kutiji s podlogom imitacije baršuna. Savršeno očitavanje skale pomoću crvene kazaljke. Proizvedeno u Njemačkoj.
02.7.1685.00
Prozirni plastični krakovi mogu se pomicati oko zajedničke osi. Glava se može rotirati za 360° i ima tri skale kalibrirane prema ISO normi (međunarodna organizacija za standardizaciju).


Osvijetljena kutija za tablice za ispitivanje vida
Šifra
02.7.4982.00
02.7.0468.00
Osvijetljena kutija za tablice za ispitivanje vida. Kutija se može postaviti na zid. Tablice za ispitivanje vida ne dolaze uz kutiju. Kupuju se zasebno.
02.7.4982.00 | 1 stupac, 24 x 65cm
02.7.0468.00 | 2 stupca 69x69 cm


Osvijetljena tablica za ispitivanje vidne oštrine
Šifra
02.7.1119.00
Unutarnje osvjetljenje Jedan stupac 96×30 cm. Bez pleksiglasa.

Papirnate tablice za ispitivanje vida, za 5 metara udaljenosti
Šifra
02.7.0854.00
02.7.0294.00
02.7.5350.00
02.7.0854.00 | sa sličicama, dječja
02.7.0294.00 | ”S” kukicama
02.7.5350.00 | s brojkama



Stereo test po Langu
Šifra
02.7.5353.00
02.7.1240.00
02.7.5353.00 | Test I. mačka
02.7.1240.00 | Test II. slon
Ishihara - 14 slika
Šifra
02.7.1282.00
Ishihara knjiga s testovima raspoznavanja boja. 14 slika.



Tablice za ispitivanje vida od pleksiglasa, s dvije vrste optotipa (tablica kettesy)
02.7.4771.01 02.7.4771.08 Brojke / slova
02.7.4771.02 02.7.4771.09 Brojke / sličice 02.7.4771.03 02.7.4771.10 Brojke / “E”kukice
02.7.4771.04 02.7.4771.11 Slova / sličice
02.7.4771.05 02.7.4771.12 Slova / “E”kukice
02.7.4771.06 02.7.4771.13 “E”kukice / sličice
02.7.4771.07 02.7.4771.14* “E”kukice / brojke
Tablica za ispitivanje vida, jedna vrsta optotipa (tablica Kettesy)
02.7.4755.08 02.7.4755.04 Brojke 02.7.4755.09 02.7.4755.05 “E”kukice
02.7.4755.10 02.7.4755.06 Slova
02.7.4755.11 02.7.4755.07 Sličice



Njemačka kvaliteta

Mikrokirurška neurološka spinalna kirurgija

Osteosinteza

Opća kirurgija

Sustav za klipse aneurizmi

Kraniomaksilofacialna osteosinteza

Kardiovaskularna kirurgija


Sustavi sterilizacijskih posuda Laparoskopija

KIRURŠKE pincete
Kirurška pinceta sa zupcima za držanje i hvatanje tkiva. Izrađene od nehrđajućeg čelika.

10.120.14 14 10.120.16 16
10.120.20 20 10.120.30 30 Šifra



ANATOMSKE pincete
Anatomska pinceta ima tupe i zaobljene krakove. Služi za hvatanje krvnih žila i živaca. Izrađene od nehrđajućeg čelika.

Šifra
10.102.11 11,5 10.102.13 13
10.102.14 14,5
10.102.16 16
10.102.18 18
10.102.20 20 10.102.23 23
10.102.25 25 10.102.30 30


Izrađene od nehrđajućeg čelika.

05.1.0193.00 14
05.1.0194.00 16
05.1.0942.00 18
05.1.0505.00 20
05.1.0675.00 25 05.1.1074.00 30

Pincete po ADSONU
Služi za hvatanje krvnih žila i živaca, vađenje stranih tijela i male kirurške zahvate. Izrađene od nehrđajućeg čelika.

12 10.170.15 15 Šifra Vel (cm) 10.120.11 11,5 10.120.13 13
Izrađene od nehrđajućeg čelika.


Izrađene od nehrđajućeg čelika.

Pinceta po ADSONU

Pincete po LUCAEU | ušne
Koristi se za intraauralne zahvate

44.206.14 14
44.206.16 16
44.206.18 18
Izrađene od nehrđajućeg čelika.


Pincete po TROELTSCHEU | ušne
Koristi se pri otorinolaringološkim zahvatima

Izrađene od nehrđajućeg čelika.


Pinceta za uklanjanje krpelja

Pinceta za vađenje špranji

Pinceta za vađenje špranji duljine 11,5 cm, s oštrim vrhovima za lakše primanje i odstranjivanje stranih tijela.

Kirurške škare se koriste prvenstveno za rezanje tkiva, šavova te medicinskih potrošnih materijala poput zavoja i kompresa. Načinjene su od vrhunskog nehrđajućeg čelika, a dolaze u nekoliko različitih duljina, te u ravnim i zakrivljenim varijantama sa svim konfiguracijama vršaka (Tupo-tupe; Šiljato - tupe; Šiljato - šiljate)
Rebstock | Standardne | RAVNE




Rebstock | Standardne | ZAKRIVLJENE

Standardne | RAVNE



Standardne | ZAKRIVLJENE

Goldman-Fox škare se uglavnom koriste pri dentalnim zahvatima za rezanje gingive, te se koristi u plastičnoj kirurgiji ili hemooidektomiji te drugim rektalnim zajvatima. Jedna od oštrica je sitno nazubljena, što omogućava bolje prianjanje uz tkivo. Dostupne kao ravne i zakrivljene, duljine 13 cm. Izrađene od nehrđajućeg čelika.




Iris škare su dizajnirane za oftamološke zahvate, ali se također koriste u raznim drugim kirurškim zahvatima. Idealne su za detaljno seciranje osjetljivog tkiva i otklanjanje konaca, a koriste se i u ustanovama za hitnu pomoć te za ginekološke i dermatološke zahvate



Škare koje se koriste za epiziotomiju tijekom trudova i porođaja Škare su nakošene te imaju tupe vrhove, a dolaze u različitim duljinama. Izrađene od nehrđajućeg čelika

Očne za IRIS Po BRAUN-STADLERU | za epiziotomiju Po LISTERU | za zavoje i gips


SPENCERU | za vađenje konca
Koriste se za uklanjanje konaca. Škare imaju mali kukasti vrh na jednoj od oštrica pomoću kojeg se konac može lagano podići prije presijecanja odnosno uklanjanja. Kukica također drži konac tako da ne sklizne s oštrice škarica prije presijecanja. Dostupne u dvije varijante po dužini. Izrađene od nehrđajućeg čelika.



Škare za zavoje po Listeru se obično koriste pri rezanju i oblikovanju zavoja te otklanjanju kompresa. Također se koriste i za rezanje čvrstih materijala poput gipsa, tkanine a ponekad i pupčane vrpce. Oštrice škara su nakošene s time da je donja oštrica malo dulja od gornje. Vršak donje oštrice je plosnat i tup kako bi se lakše mogao uvući između zavoja i kože bez rizika da ju poreže. Ponekad se koriste pri carskom rezu kod otvaranja maternice kako bi se izbjeglo ozljeđivanje djeteta. Dostupne u četiri veličine, izrađene od nehrđajućeg čelika.



Metzenbaum škare dostupne su u dvije varijante po obliku - zakrivljene i ravne, te u nekoliko različitih dužina. Namijenjene su za rezanjeosjetljivog i delikatnog tkiva. Same škare imaju veoma duge drške u odnosu na oštrice. Ovaj tip škarice je najčešće korišten u većini operacija organa te u operativnih zahvatima srca.
RAVNE
RAVNE Po METZENBAUMU | Tupo-tupe






Zlato je jedan od najbiokompatibilnijih metala za oblaganje medicinske opreme jer smanjuje rizik od postoperativnih infekcija, ne izaziva reakcije u kontaktu s kožom, tkivom i unutarnjim organima. Posjeduje idealna izolacijska svojstva, lako ga je oblikovati, otporno je na stvaranje korozije. Toliko je gusto da kroz njega ne prolazi X-zračenje, izniman je vodič i upečatljive boje.

Škarw Goldman-Fox RAVNE


Pinceta anatomska po ADSONU Škare





Hvatalica po MOSQUITU
Hvatalice po Mosquitu su hemostati s okruglim prstenastim drškama te nazubljenim vršcima. Koriste se za razne kirurške zahvate, primjerice za zaustavljanje krvarenja kod površinskih ozljeda.
RAVNE RAVNE






ZAKRIVLJENE

Hvatalice po CRILEU
Hvatalica koja se najčešće koristi za uklještavanje žila ili tkiva prije kauterizacije ili ligacije. Vodoravni rezovi duljinom cijelog vrha koji su pola duljine drške čine jedan veoma unikatan instrument. Zupčani mehanizam zaključavanja omogućuje čvrst i postojan hvat žila. Može se koristiti i za seciranje mekanog tkiva ne debljeg od 20 cm te u laparoskopskim zahvatima.
RAVNE

ZAKRIVLJENE

Hvatalice po KOCHERU

RAVNE

Hvatalica za arterije po Kocheru s unutarnje strane ima zubac, a na suprotnoj strani ležište. Namijenjena je za agresivno hvatanje srednje do teškog tkiva ili zatvaranje teških i gustih krvnih žila. Oba kraka su unutarnjom dužinom izbrazdana dok se na vrhu nalazi zubac što omogućava čvrsto držanje tkiva ili arterije.

RAVNE RAVNE

ZAKRIVLJENE ZAKRIVLJENE



Hvatalica po PEAN-ROCHESTERU
Hemostatska hvatalica po Rochester-Peanu se koristi za stezanje većih žila i tkiva radi hemostaze. Rezovi duljinom cijelog vrha te dostupnost u različitim duljinama čine ovu hvataljku višenamjenski korisnim instrumentom korištenim u velikom broju zahvata. Dostupne u ravnoj i zakrivljenoj varijanti. Izrađene od nehrđajućeg čelika.





Hvatalica po COLLINU


Hvatalica za jezik po Collinu se koristi u oralnoj i laringalnoj kirurgiji. Dostupna u dvije različite duljine. Izrađena od nehrđajućeg čelika.



Hvatalica po Dandyju je zakrivljena sa strane te s nazubljenjima na krakovima. Ova hvatalica se može koristiti pri općim zahvatima za hemostazu. Izrađena od nehrđajućeg čelika.


Hvatalica po Overholtu je instrument s mehanizmom za zapinjanje koji se koristi za niz zahvata, prvenstveno za hvatanje krvnih žila te kontrolu krvotoka. Fig. 0



Hvataljke po Leriche imaju prstenaste drške i mehanizam za zaključavanje pri držaljci, te se koriste za stezanje žila i kontroliranje protoka krvi. Izrađene od nehrđajućeg čelika.

Dostupno u dvije različite duljine. Nazubljeni vršci omogućuju siguran hvat za ga ze, zavoje, vatu i ostale materijale za pre vijanje. Izrađena od nehrđajućeg čelika.


Hvatalica za vađenje stranih tijela
Hvatalica koja se prvenstveno koristi za uklanjanje stranih tijela iz nosa i ušiju. Izrađena od nehrđajućeg čelika.


Hvatalica po MAGILLU
HARTMANNU

Hvatalica po Magillu se koristi za držanje tubusa te postavljanje vrha u šupljinu. Vršci hvatalice su nazubljeni te treba biti pažljiv da se njima ne ošteti tubus prilikom rukovanja.
Duljina (cm) Šifra

Hvatalica za rublje po BACKHAUSU

Duljina (cm)
Iglodržači po MAYO HEGARU

Hvatalica za arterije po HALSEYU Po BUCKU


Hvatalica za spužvu, ravna
Sterilna. Jednokratna.
Hvatalica za spužvu, ravna


Stezaljka koja se koristi za pridržavanje ručnika i tkanine, hvatanje tkiva te pridržavanja ili uklanjanja manjih koštanih fraktura.

Iglodržač po Mayo Hegaru je podesivi instrument s okruglim drškama koji se koristi za niz kirurških procedura. Izrađen od nehrđajućeg čelika.





Iglodržač po MATHIEU
kod preciznijeg i profinjenijeg šivanja



Kliješta po WINTERU
Kliješta (hvatalica) po Winteru se koristi u ginekologiji i opstetriciji za zahvate vezane za posteljicu i maternicu.

Kliješta po NOTU
Koristi za hvatanje i otklanjanje polipa iz maternične šupljine. Također se koristi i za pridržavanje spužvice te kao opći stabilizator za pridržavanje mekanog tkiva.




Tenakulum po SCHROEDER-POZZIJU
Kliješta za polipe po DOYENU
Koristi se za hvatanje i otklanjanje polipa. Koristi se i kao hvatalica za spužvu te tijekom zahvata za pridržavanje gaze.


Koristi se pri ginekološkim zahvatima rodnice i maternice, te za vaginalnu i abdominalnu histerektomiju.


po SCHROEDERU

Ginekološki instrument koji se koristi pri zahvatima na rodnici poput epiziotomije, histerektomije te za dilataciju i kiretažu.


Kliješta za biopsiju po ALEXANDERU
Kliješta za biopsiju po Alexanderu koriste se pri biopsiji kritičnih dijelova tkiva koji su teže dostupni. Izrađena su od nehrđajućeg čelika.


Kliješta za gips po BRUNSU
Kliješta za gips koriste se za skidanje gipsa i srodnih mu materijala. Dolazi u glatkoj i nazubljenoj varijanti.

Kliješta za biopsiju po SCHUBERTU
Kliješta za biopsiju koriste se za uzimanje uzoraka sa stijenke cerviksa ili s ruba cervikalnog otvora. Izrađena su od nehrđajućeg čelika.




Kliješta za nokte po TURNBULLU
Služe za uklanjanje dijelova nokta nožnog palca ili cijelog nokta. Instrument ima bačvastu oprugu te ručke s mehanizmom za zaključavanje koji se otpušta stiskanjem. Izrađena su od nehrđajućeg čelika.


Vaginalni spekulumi po CUSCOU
Vaginalni spekulum po Cuscou je samodržeći spekulum koji se koristi za pregled ili zahvate unutar vaginalnog kanala. Plohe spekuluma se otvaraju, zatvaraju i postavljaju pomoću za to namijenjenog vijka. Postoje tri glavne podvrste spekuluma: Standardni - Plosnatiji rub pri vrhu - kraći od Swiss modela. Model s centralnim vijkom spada pod ovu kategoriju, s jedinom razlikom da se dodatni vijak nalazi na sredini te omogućuje bolju kontrolu spekuluma. Swiss - Blago širi nego nego standardni model, ravnomjerno zaobljen cijelom dužinom. Virgo - Najuži i najmanji model, namijenjen prvenstveno za pedijatrijske pacijente.
Standardni

75 x 35 mm
85 x 35 mm
100 x 35 mm

Standardni

75 x 32 mm
85 x 35 mm
100 x 35 mm

Vaginalni spekulumi po KRISTELLERU
Spekulum po Kristelleru je ginekološki instrument namijenjen za manualne preglede. Svi spekulumi su izrađeni od vrhunskog nehrđajućeg čelika njemačke kvalitete.


x 25 mm
x 27 mm
x 30 mm


Dimenzije
90 x 25 mm 05.1.0987.02
100 x 27 mm 05.1.0987.03 110 x 30 mm 05.1.0987.04

Vaginalni spekulumi po SIMSU
Izrađeni od nehrđajućeg čelika. Upotreba zahtijeva asistenciju druge osobe, no ovaj model spekuluma pruža bolju preglednost prilikom pregleda.




Vaginalni spekulumi po BREISKYJU
Spekulum po Breiskyju je instrument koji se koristi pri pregledu vaginalnog kanala. Dostupan u nekoliko dimenzija, izrađen od nehrđajućeg čelika.




Dilatator po HEGARU
Dilatori za uterus po Hegaru se su vrsta instrumenata koja se prvenstveno upotrebljava u ginekološkim pregledima uterusa. Nehrđajući čelik - njemačka kvaliteta.

Promjer (mm) Šifra
1,5 70.415.01
2,5 70.415.02
3,5 70.415.03
4,5 70.415.04
5,5 70.415.05
6,5 70.415.06
7,5 70.415.07
8,5 70.415.08
9,5 70.415.09
10,5 70.415.10
11,5 70.415.11
12,5 70.415.12

Pelvimetar po MARTINU
Pelvimetar po Martinu, namijenjen za pelvimetrijski pregled zdjelice pri ginekološkim pregledima.



Sonde za uterus po MARTINU
Koristi se za pregled i dilataciju uterusa kao i za mjerenje duljine rodnog kanala. Obje varijante su izrađene od nehrđajućeg čelika.

Vrsta instrumenata koja se prvenstveno upotrebljava u ginekološkim pregledima uterusa. Dilatori su čvrsti i nefleksibilni.
Promjer (mm) Šifra
1 05.1.1459.01
1,5 05.1.1459.02
2 05.1.1459.03
2,5 05.1.1459.04
3 05.1.1459.05
4,5 05.1.1459.08
5 05.1.1459.09
5,5 05.1.1459.10
6 05.1.1459.11
7 05.1.1459.13
8 05.1.1459.15 11 05.1.1459.21 12 05.1.1459.23 14 05.1.1459.27 25 05.1.1459.41

Kohlea po SIMONU
Kohlea po Simonu ima oštri grebenasti zaobljeni vrh te je namijenjena za odstranjivanje tkiva s rubova maternice. Dostupna u nekoliko varijanti, izrađena od nehrđajućeg čelika.


Sonde za uterus po SIMSU
Koristi se za pregled i dilataciju uterusa kao i za mjerenje duljine rodnog kanala. Obje varijante su izrađene od nehrđajućeg čelika.



Primjenjuje se za ispitivanje, mjerenje, pregledavanje i širenje organskih šupljina. Dostupna u dvije veličine. Izrađena od nehrđajućeg čelika.


Koristi se za identificiranje, mjerenje, i pregledavanje organskih šupljina. Dostupna u dvostranoj varijanti te varijanti s proširenjem na jednom dijelu (glavičasta sonda). Dužina sonde je 16 cm.

Retraktor kapaka po DESMARRESU
Oftamološki instrument koji se koristi za podizanje kornjeg kapka i trepavica. Izrađen od nehrđajućeg čelika.




Kirete za kosti po VOLKMANU Kireta po SIMSU
Koristi se za struganje i otklanjanje vlaknastog tkiva i ostalih krhotina iz kostiju. Može se koristiti i za otklanjanje manjih dijelova kostiju. Kirete po Volkmanu dolaze u različitim veličinama.
Veličina Šifra
0000 05.1.0690.04
000 05.1.0690.03
00 05.1.0690.02
0 05.1.0690.01
1 05.1.0690.05
2 05.1.0690.06
3 05.1.0690.07

Retraktor po
Retraktor po Volkmannu koristi se za povlačenje, izlaganje ili guranje tkiva, mišića, organa ili kosti tijekom operacije.

Koristi se za čišćenje stjenki apscesnih šupljina. Izrađena je od nehrđajućeg čelika.


Kohlea po WILLIGERU
Instrument koji se koristi za male periodontalne zahvate te za zahvate vezane uz kosti. Izrađena od nehrđajućeg čelika.

Metalna žica presvučena plastikom koja se koristi za lakše umetanje i vađenje trahealnog i faringealnog tubusa, odnosno intubaciju. Stileti su pakirani zasebno.


Kanila po KILLIANU Otvarači za usta po HEISTERU
Namijenjena za aspiraciju i irigaciju nosa.



Nosni spekulum po KILLIANU
Nosni spekulum za pregled nosne šupljine. Ovaj instrument ima mehanizam s vijcima za fiksiranje pomoću kojih se spekulum može zaključati u otvoreni položaj te time omogućiti korištenje jedne slobodne ruke. Spekulum ima uklještenu dršku s jednostrukom oprugom.

ŠTRCALJKA za ispiranje uha
Namjena: za uklanjanje cerumena i nečistoća iz uha.

Uređaj s magnetom za vađenje stranog tijela iz oka, 14 cm


Metalni trodijelni štitnik za prst

Špatule za jezik - za preglede usta i otofaringealne zahvate. Dužine od 14 i 19 cm.

Nosni spekulumi po

Spekulumi namijenjeni za širenje nosnica pri čemu se pruža bolja vidljivost prilikom pregleda. Koristi se za osnovne preglede ali i za zahtjevnije zahvate.

za uho po REINERU
Namijenjena za odstranjivanje cerumena iz uha. Izrađena od nehrđajućeg čelika.
Izrađena je od nehrđajućeg čelika te je ergonomski oblikovana za lakše rukovanje. Sve štrcaljke su lako perive i jednostavno se rastavljaju i sastavljaju.
Plastična štrcaljka
Ekstraktor za akne Štrcaljka za uho po SCHIMMELBUSCHU





Aplikator za vatu


Metalni ušni lijevak, set od 3 komada SKALPEL-NOŽIĆ od nehrđajućeg čelika


Drška za skalpel


Metalna ogledala za grlo se koriste pri pregledu usne šupljine, odnosno zuba, usta, ždrijela i grla. U ponudi se nalazi nekoliko različitih modela raznih promjera ogledala. Sva ogledala su pojedinačno pakirana.

Jednokratni STERILNI NOŽIĆI
DRŠKA za ogledalo za grlo

Jednokratni STERILNI SKALPELI
Jednokratni nožići od nehrđajućeg čelika (prema ISO 7153 i ISO 7740 standardu) debljine 0.40 mm. Sterilizirano gama zračenjem. Pojedinačno pakovano. Pakovanje: kutija sa 100 komada. Skalpel s nožićem od nehrđajućeg čelika (prema ISO 7153 i ISO 7740 standardu) debljine 0.40 mm. Plastična drška sa sigurnosnim mehanizmom. Sterilizirano gama zračenjem. Pakovanje: kutija s 10 komada.






Mali KIRURŠKI SET u torbici
• anatomska pinceta 16 cm,
• drška za skalpel i nožić veličine 3,
• škare ravne 14cm, kirurške škare ravne 14 cm, kirurške škare savijene T.Š. 14 cm,
• hvatalica za arterije - savijena 14 cm, ravna 16 cm, savijena 16 cm,
• dvostrana sonda - ravna i s proširenjem na jednom kraju,
• iglodržač po Mathieu, igla za šivanje, kirurški konac s iglom Dafilon 3/0,
• torbica sa zip zatvaračem

Jednokratne sterilne skalpel oštrice
Sterilizirane su gama zračenjem i zapakirane u aluminijske sterilne spremnike. Oštrice se razlikuju po obliku i namjeni, a prvenstveno se koriste za rezanje tkiva i šavova. Pakovanje sadrži 100 oštrica.

Skalpel (plastična drška + nožić) sterilni
Jednokratni skalpeli s drškom. Namijenjeni za jednokratnu upotrebu. Pakovanje sadrži 10 komada.

Bubnjevi za sterilizaciju | TITANOX
Bubnjevi za sterilizaciju izrađeni od visokokvalitetnog nehrđajućeg čelika. Pogodni za sterilizaciju u autoklavu i suhom sterilizatoru.
Dimenzije (mm) Šifra
125 x 80 A1-001-125
125 x 100 A1-002-125
125 x 125 A1-003-125
150 x 80 A1-004-150
150 x 100 A1-005-150
150 x 130 A1-006-150
150 x 150 A1-007-150
150 x 190 A1-008-150
190 x 125 A1-009-190
190 x 145 A1-010-190
190 x 165 A1-011-190
190 x 190 A1-012-190
190 x 240 A1-013-190
240 x 165 A1-017-240
240 x 240 A1-019-240
290 x 165 A1-024-290
290 x 190 A1-025-290
290 x 290 A1-027-290
340 x 165 A1-031-340
390 x 240 A1-040-390



Bubrežaste zdjelice
Bubrežaste zdjelice izrađene od visokokvalitetnog nehrđajućeg čelika.
Bubrežaste zdjelice s poklopcem
Koristi se kao pomoćno sredstvo za odlaganje nečistog pribora i kao pomoćni pribor za izlučevine.


Bubrežasta zdjelica, plastična 26 cm

Kartonska bubrežasta zdjela

Kutije za sterilizaciju od nehrđajućeg čelika | TITANOX
Kutije za sterilizaciju izrađene od visokokvalitetnog nehrđajućeg čelika.
Dimenzije (mm) Šifra
180 × 80 × 40 A2-168-180
200 × 100 × 50 A2-169-200
220 x 120 x 60 A2-170-220
250 x 120 x 60 A2-171-250
300 x 120 x 60 A2-172-300
320 x 150 x 60 A2-173-320
400 × 160 × 70 A2-174-400


Aluminijske kutije za sterilizaciju instrumenata | TITANOX
Kutija za sterilizaciju i pohranu od aluminija posebno je otporna i dugovječna. Namijenjena je sterilizaciji kirurških instrumentata u autoklavu ili suhom sterilizatoru.
A1-110-255

Tacne za instrumente | TITANOX
Tacne za instrumente izrađene od visokokvalitetnog nehrđajućeg čelika.
Dimenzije (mm) Šifra
200 × 150 × 25
260 × 180 × 30
350 × 250 × 40
A5-271-200
A5-272-260
A5-274-350



Posuda za držanje instrumenata u alkoholu
Posuda za alkohol od nehrđajućeg čelika, dostupna u tri različite varijante.

Dimenzije (mm) Šifra
30 × 90 88.142.01
50 × 130 88.142.03
75 × 100 88.142.05

Posude za odlaganje, inox



Posuda okrugla, inox
Okrugla posuda od nehrđajućeg čelika, dostupna u tri različite varijante.
Dimenzije (mm) Šifra
165 × 60 88.133.16
175 × 70 88.133.17
220 × 80 88.133.22



Okrugle zdjelice, inox | s poklopcem
Zapremnina (ml) Šifra
30 05.2.2701.00 50 05.2.2702.00
150 05.2.2547.00 250 05.2.2548.00

Okrugle zdjelice, inox | bez poklopcem
Zapremnina (ml) Šifra
30 05.2.1995.00
50 05.2.1996.00
150 05.2.1997.00
250 05.2.1998.00
Okrugla posuda, inox
Posuda namijenjena uporabi u liječničkoj ordinaciji. Ravno dno, s izljevom, promjer 60 mm.
A5-253-006

Staklene mjerne posude

Posuda za vatu
Posuda za vatu od inox-a, okrugla s poklopce s ručkom. Promjer 12cm i 12cm visine. Namijenjena držanju vate u liječničkim ordinacijama.
A5-289-120

Izbor staklenih mjernih posuda različitih zapremina i oblika. Prvenstveno namijenjene za laboratorijsku upotrebu. Posude su pakirane pojedinačno.
Zapremnina (ml) Šifra 50 03.4.2380.00 100 03.4.2381.00
250 03.4.1507.00
400 03.4.2382.00
600 03.4.2273.00
800 03.4.1505.00
1000 03.4.1504.00
2000 03.4.2406.00
3000 03.4.2407.00


Sterilizator vrućim zrakom Titanox Pasteur
Šifra Opis
A3-213-400 20 l | 570x345x400 mm (vanjska dimenzija) 405x255x210 mm (unutarnja dimenzija)
A3-214-535 60 l | 705x450x475 mm (vanjska dimenzija) 535x320x345 mm (unutarnja dimenzija)
A3-215-670 120 l | 835x565x555 mm (vanjska dimenzija) 670x420x415 mm (unutarnja dimenzija)
Materijal: nehrđajući čelik. Područje zatvaranja obloženo je netoksičnom silikonskom brtvom. Unutarnja toplinska izolacija napravljena je od staklenih vlakana visoke kvalitete. Uređaj je opremljen vratima sa bravom i ključem. Podesivi tuneli za prozračivanje smješteni su na dnu desne strane i na vrhu s lijeve strane poradi prilagodbe cirkulacije vrućeg zraka te lakšeg i bržeg hlađenja uređaja. Ugrađen vremenski brojač (odbrojavanje od 0 do 120 minuta). Regulator temperature s odabirom od 0° do 200°C. Sigurnosni termostat. Dvostruko kontrolno svjetlo (crveno i zeleno). 230V – 50/60 Hz.

Sterilizator vrućim zrakom Titanox Small
Šifra Opis
A3-211-300 3 l | 400x295x170 mm (vanjska dimenzija) 300x125x80 mm (unutarnja dimenzija)
A3-212-400 5 l | 500x325x170 mm (vanjska dimenzija) 400x160x80 mm (unutarnja dimenzija)
Uređaj je namijenjen za korištenje u sanitarnom okruženju za potrebe sterilizacije medicinske i kirurške opreme otporne na toplinu. Proces dezinfekcije temelji se isključivo na toplinskom uništavanju mikroorganizama prisutnih na med. opremi. Uobičajena temperatura sterilizacije iznosi 180°C. Vanjsko kučište je izrađeno od nehrđajućeg čelika. Unutarnja struktura, rešetka, uklonjiva perforirana tacna i poklopac su u potpunosti izrađeni od nehrđajućeg čelika. Unutrašnjost i poklopac su obrubljeni netoksičnim brvilom od silikonske gume te izolirani visokokvalitetnom staklenom vunom. Grijaći element je oklopljen nehrđajućim čelikom. Timer ima raspon od 0 do 120 minuta te automatski isključuje uređaj nakon isteklog postavljenog vremena. Termometar 0°- 200°C. Sigurnosni termostat. Zeleno svjetlo s desne strane signalizira liniju umetanja. Zeleno svjetlo s lijeve strane označava rad otpornika. 230V - 50/60 Hz.

Indikator traka za sterilizatore vrućim zrakom
04.1.0138.00 ITH-19
04.1.0137.00 ITH-19
Širina 19 mm, duljina 50 m. Služi za provjeru temperature. Mijenja boju na temperaturi od cca 121°C.

Uređaj za destilaciju vode
Role za sterilizaciju vrućim zrakom WIPAK

Role za sterilizaciju vrućim zrakom: poliamidna folija otporna na vatru namijenjena za sterilizaciju vrućim zrakom, bez indikatora; temperatu-
ra: maksimalno 180 °C. Dužina role je 200 metara.ga grijača: 900 W. Masa aparata (bruto/neto): 30/29 kg.
Uređaj za destilaciju vode pročišćuje vodu od stranih tvari na prirodan i djelotvoran način. Voda se postepeno zagrijava na 100°C, pritom odstranjujući viruse, bakterije te organske i anorganske kemikalije. Kemikalije, teški metali i zarazne tvari se talože na dnu uređaja, a voda se pročišćuje pomoću filtra od aktivnog ugljena. Uređaj proizvodi 4 litre 100% destilirane vode za 6 sati i to na jeftin i jednostavan način. Opremljen je automatskim termostatom sa sustavom blokiranja na kraju procesa destiliranja. Dodatna oprema: 6 filtera, 1 deterdžent, 1 spremnik za destiliranu vodu. Dimenzije: Ø 20 cm×36 cm.

Phoenix Blu LCD Printer 18-24
Šifra
GU-PH-LCD18
GU-PH-LCD24
USB priključak - Automatsko pohranjivanje podataka o sterilizaciji na USB memoriju (uključena u paketu). Ugrađeni pisač - Automatski ispis podataka o sterilizaciji na termalni papir.
Glavne funkcije:
• LCD zaslon
• stand-by funkcija
• sušenje
• 12 ciklusa sterilizacije i 3 testna ciklusa
• USB priključak i ugrađeni pisač
Tehničke karakteristike:
• Dimenzije: 462 x 445 x 600 mm
• Težina: 54/56 kg
• Dimenzije komore za sterilizaciju (18): 255 x 360 mm
• Dimenzije komore za sterilizaciju (24): 255 x 460 mm
• Temperatura sterilizacije: 121 °C - 134 °C

Phoenix Blu LCD Printer plus+ 18-24
Šifra
GU-PH-LCD+18
GU-PH-LCD+24
Automatski sustav za pročišćavanje vode reverznom osmozom
• ultra-brzi generator pare
• kvaliteta i brzina
• vakum pumpa s dvostrukom glavom
• neovisni i pristupačni spremnici
• separator zraka/vode
• brza drenažna cijev
• Radni tlak:
Ciklus 121 °C: 1,0 - 1,3 bar (STP)
Ciklus 134 °C: 2,0 - 2,4 bar (STP)
• Spremnik za vodu:
Destilirana voda: 4,6 l
Otpadna voda: 5,0 l
• Bakteriološki filter (Filter za zrak):
Promjer: ø 56 mm
Kapacitet filtracije: 0,3 μm
Phoenix Blu LED plus+ 18-24
Šifra
GU-PH-LED+18
GU-PH-LED+24
Pročišćivač vode sa sustavom osmoze - Automatski sustav za pročišćavanje vode reverznom osmozom – vertikalni sustav. Automatsko punjenje vodom - Sustav automatskog punjenja vodom izravno iz vodovodne mreže. USB priključak - Automatsko pohranjivanje podataka o sterilizaciji na USB memoriju (uključena u paketu). Ugrađeni pisač - Automatski ispis podataka o sterilizaciji na termalni papir.
Glavne funkcije:
• LED zaslon
• stand-by funkcija
• sušenje
• 14 ciklusa sterilizacije i 3 testna ciklusa
• USB priključak i ugrađeni pisač
Tehničke karakteristike:
• Dimenzije: 462 x 445 x 600 mm
• Težina: 54/56 kg
• Dimenzije komore za sterilizaciju (18): 255 x 360 mm
• Dimenzije komore za sterilizaciju (24): 255 x 460 mm
• Temperatura sterilizacije: 121 °C - 134 °C

• ultra-brzi generator pare
• kvaliteta i brzina
• vakum pumpa s dvostrukom glavom
• neovisni i pristupačni spremnici
• separator zraka/vode
• brza drenažna cijev
• Radni tlak:
Ciklus 121 °C: 1,0 - 1,3 bar (STP)
Ciklus 134 °C: 2,0 - 2,4 bar (STP)
• Spremnik za vodu:
Destilirana voda: 4,6 l
Otpadna voda: 5,0 l
• Bakteriološki filter
(Filter za zrak):
Promjer: ø 56 mm
Kapacitet filtracije: 0,3 μm

– vertikalni sustav. Automatsko punjenje vodom - Sustav automatskog punjenja vodom izravno iz vodovodne mreže. USB priključak - Automatsko pohranjivanje podataka o sterilizaciji na USB memoriju (uključena u paketu). Ugrađeni pisač - Automatski ispis podataka o sterilizaciji na termalni papir. Pročišćivač vode sa sustavom osmoze.
Glavne funkcije:
• LCD zaslon
• stand-by funkcija
• sušenje
• 12 ciklusa sterilizacije i 3 testna ciklusa
• USB priključak i ugrađeni pisač
Tehničke karakteristike:
• Dimenzije: 462 x 445 x 600 mm
• Težina: 54/56 kg
• Dimenzije komore za sterilizaciju (18): 255 x 360 mm
• Dimenzije komore za sterilizaciju (24): 255 x 460 mm
• Temperatura sterilizacije: 121 °C - 134 °C
• ultra-brzi generator pare
• kvaliteta i brzina
• vakum pumpa s dvostrukom glavom
• neovisni i pristupačni spremnici
• separator zraka/vode
• brza drenažna cijev
• Radni tlak: Ciklus 121 °C: 1,0 - 1,3 bar (STP) Ciklus 134 °C: 2,0 - 2,4 bar (STP)
• Spremnik za vodu: Destilirana voda: 4,6 l Otpadna voda: 5,0 l
• Bakteriološki filter (Filter za zrak): Promjer: ø 56 mm Kapacitet filtracije: 0,3 μm
Autoclave klase N - HYDRA 100 automatic
Šifra
GU-HYDRA100
KLASA N – Sterilizacija instrumenata. Hydra 100 mali parni autoklav prikladan je za sterilizaciju čvrstih, nezapakiranih instrumenata. Iako autoklavi klase N imaju ograničenja u pogledu vrste instrumenata koje mogu sterilizirati, posjeduju mnoge prednosti poput manje veličine, brzine ciklusa, pouzdanosti, te povoljnije cijene. Autoklavi su sterilizatori koji koriste tri ključna čimbenika za postizanje potpune aseptičnosti instrumenata: TEMPERATURU, PRITISAK I ZASIĆENU PARU. Zahvaljujući kombinaciji ovih triju faktora u zatvorenom spremniku, sterilizacija se odvija brzo, uz najvišu razinu učinkovitosti.
Specifikacije proizvoda:
• Vrsta autoklave: UNI EN 13030, klasa N
• KLASA IIB
• Dimenzije sterilizacijske komore: 210 x 215 mm
• Vanjske dimenzije: 290 x 310 x 385 mm
• Kapacitet sterilizacijske komore: 9 litara

• Temperatura sterilizacije: 125°C
• Pritisak sterilizacije: 1,3 bara
• Trajanje ciklusa sterilizacije: 15 minuta
• Maksimalna temperatura: 130°C
• Maksimalni pritisak: 2,2 bara
• Težina: Neto 13 kg, bruto 16 kg
• Napon: 220 V
• Potrošnja energije: 1500 W
MELAG | Pro Line: Vacuclave 123 | 23 L, Klasa S
Šifra
MEL-Vacuclav123-23
Ako ste upoznati s najprodavanijim autoklavama MELAG Pro-klase tada ćete zasigurno zavoljeti novu generaciju MELAG uređaja – od funkcionalnosti do cijene! S naprednim konceptom upravljanja i dokumentacije te modernim i izrazito robusnim dizajnom, autoklavi Pro Line linije nude sve što vam je potrebno za sigurnu, praktičnu i resursno učinkovitu sterilizaciju. Ova se njemačka tvrtka od 1951. godine u sjedištu u Berlinu bavi razvojem, proizvodnjom i optimizacijom svojih proizvoda prema najvišim standardima kvalitete.
Tehničke karakteristike:

• Snažan proces u klasi S: pouzdana sterilizacija do 6 kg na 5 ladica u samo 15 do 27 minuta (s dodatnim sušenjem na određeno vrijeme).
• Pametni dodirni zaslon s LED statusom: zaslon osjetljiv na dodir s intuitivnom strukturom izbornika za jednostavno rukovanje, slično kao kod pametnog telefona.
• Povezivost i bilježenje podataka: usklađenost sa zakonskim zahtjevima pohranjivanjem parametara sterilizacije putem USB-a ili mreže.
• Koncept samostalnog rada: integrirani spremnici za vodu i visokoučinkovito zračno hlađenje za neovisnost od vanjskog hlađenja vodom.
• Ušteda energije u načinu rada Power Save: grijanje i prikaz ulaze u stanje pripravnosti između sterilizacija za maksimalnu energetsku učinkovitost.
• EasyCare koncept rutinske njege: korisnički optimizirani sustav za učinkovitu zamjenu filtera, čišćenje spremnika i opskrbu vodom.

DXP Domina je osmišljena na temelju ključnih značajki koje suvremeni autoklav mora pružati profesionalcima i njihovim timovima. To je jasno od trenutka kada primijetite njen elegantan, kompaktan dizajn. Sposobna osigurati sterilizacijske cikluse klase B i klase S s impresivnom fleksibilnošću, tek s vremenom postaju očite sve kvalitete ovog autoklava. DXP Domina izuzetno je robusna, a materijali su vrhunske kvalitete Prostrana bakrena komora osigurava izvrsnu nosivost i brzo, ravnomjerno zagrijavanje, dok Adaptive Heat sustav eliminira temperaturne fluktuacije, omogućujući sterilizaciju i najosjetljivijih instrumenata, poput zračnih turbina i ručnih komada, smanjujući rizik od njihovog oštećenja na minimum.
MELAG | Pro Line: Vacuclave 118 | 17 L, Klasa B
Šifra
MEL-Vacuclav118-17
Ako ste upoznati s najprodavanijim autoklavama MELAG Pro-klase tada ćete zasigurno zavoljeti novu generaciju MELAG uređaja – od funkcionalnosti do cijene! S naprednim konceptom upravljanja i dokumentacije te modernim i izrazito robusnim dizajnom, autoklavi Pro Line linije nude sve što vam je potrebno za sigurnu, praktičnu i resursno učinkovitu sterilizaciju. Ova se njemačka tvrtka od 1951. godine u sjedištu u Berlinu bavi razvojem, proizvodnjom i optimizacijom svojih proizvoda prema najvišim standardima kvalitete.

Tehničke karakteristike:
• Snažan vakuumski proces klase B: pouzdana sterilizacija do 6 kg na 5 ladica u samo 15 do 27 minuta (s dodatnim sušenjem na određeno vrijeme).
• Pametni dodirni zaslon s LED statusom: zaslon osjetljiv na dodir s intuitivnim izbornikom za lako rukovanje, slično pametnom telefonu.
• Povezivost i zapis podataka: poštivanje zakonskih zahtjeva pohranjivanjem parametara sterilizacije putem USB-a ili mreže.
• Koncept samostalnog rada: integrirani spremnici za vodu i učinkovito zračno hlađenje omogućuju neovisnost od vanjskog hlađenja vodom.
• Power Save način štednje energije: grijanje i zaslon prelaze u stanje mirovanja između sterilizacija za maksimalnu energetsku učinkovitost.
• EasyCare koncept rutinske njege: optimizirani sustav za jednostavniju zamjenu filtera, čišćenje spremnika i opskrbu vodom.
DXP DOMINA

DXPclave kombinira tehnologiju pare nove generacije s maksimalnom pouzdanošću Tih i jednostavan za korištenje, ističe se svojom kapacitetom i dizajnom, postajući pouzdan i učinkovit saveznik. S većim odjeljkom za instrumente i 5 različitih ladica dizajniranih za poboljšanje kapaciteta, DXPclave omogućava iskorištavanje cijele komore, jamčeći najbolji kapacitet za sterilizaciju u svojoj kategoriji (24 L). Struktura DXPclave-a dizajnirana je za brzo i učinkovito generiranje pare, dok se rizik od začepljenja sprječava zahvaljujući zavojnici od nehrđajućeg čelika i optimizaciji faze sušenja rasporedom ladica. S DXPclave-om, izvještaji o ciklusu mogu se spremiti na USB ili povezanu web platformu zahvaljujući ugrađenoj Ethernet vezi.
Lafomed | uređaj za zavarivanje vrećica

Impulsni uređaj za pripremu paketa od papirne folije neophodan je dio opreme specijaliziranih ordinacija, uključujući kozmetičke, medicinske i tattoo salone. Provođenje sterilizacije u paketima smatra se posebno učinkovitom, sigurnom i praktičnom metodom. Štoviše, omogućuje vam čuvanje sterilnih alata do 6 mjeseci nakon zahvata. Napon: 220-240V, snaga: 780W, maksimalna duljina zavarivanja: 300 mm, širina zavarivanja: 12 mm, boja: nijanse bijele.
Lafomed | uređaj za zavarivanje vrećica

Zahvaljujući aparatu za zavarivanje, pribor se može staviti u sigurno, sterilno pakiranje. Nakon ovog postupka ostaju sterilni do 6 mjeseci. Rad aparata za zavarivanje je intuitivan, a metalni dijelovi uređaja izrađeni su od nehrđajućeg čelika, što osigurava dug radni vijek i olakšava održavanje čistoće. Temperatura zavarivanja je podesiva. Napon 220 V / 50 Hz, snaga 500 W, dužina vara 300 mm, širina vara 10 mm, težina uređaja 5 kg, težina uređaja u paketu 8 kg, dimenzije ambalaže 440 x 320 x 160 mm.
MELAseal 100+ uređaj za zavarivanje vrećica

Indikatorom spremnosti za zavarivanje nakon faze zagrijavanja sada se upravlja elektronički, a završetak faze zagrijavanja označava se zvučnim signalom. Novom elektronikom također se kontrolira kvaliteta rezultata zavarivanja, a eventualno loše zavaren spoj označava se zvučnim i optičkim signalom. Završetak zavarivanja označuje se elektronički. Aluminijska brtvena traka. Ugrađeni rezač omogućuje rezanje folije na željenu duljinu. Vrijeme zagrijavanja: cca 2 min. Širina zavarenog spoja: 10 mm. Vrijeme zavarivanja: 2 sekunde. Težina: 5,5 kg. Dim.: 42 × 40 × 25 cm. Napajanje: 230 V/50 Hz / 510 W. Standardna širina role (max. 25 cm). Namijenjeno samo za role za sterilizaciju parom!
Wipak IS 250 uređaj za toplinsko zavarivanje vrećica

Neprekidno zavarivanje. Ugrađen držač za role i rezač; namijenjeno za role za sterilizaciju parom i vrućim zrakom. Ravnomjeran pritisak pri svakom zavarivanju, bez perioda predzagrijavanja; zvučni i svjetlosni indikatori završetka zavarivanja; praktični držač za role, timer koji se kontrolira elektronički; ugrađeni cirkularni rezač s rotirajućom oštricom. Uređaj istovremeno reže i zavaruje, prikladan je za zatvaranje svih vrsta materijala za pakiranje, vrijeme zavarivanja može se podesiti ovisno o vrsti i debljini materijala. Ne preporučuje se za složene role. Dimenzije: 22 × 42 ×30 cm. Maksimalna širina zavarivanja: 25 cm. Snaga: 870 W. Težina: 10 kg
materijal za autoklave
Role za sterilizaciju parom WIPAK (200m) Indikator traka za autoklave
04.1.1411.00 | R40-3P
04.1.1466.00 | R41-3P

Omot treba odrezati na prikladnu veličinu, uložiti instrument, zatvoriti uređajem za zavarivanje, a zatim provesti kroz postupak sterilizacije. Role su dostupne u dvije širine - R40-3P 75 mm i R413P 100mm. Dužina rola je 200 m.

Širina 19 mm, duljina 50 m. Služi za provjeru temperature. Mijenja boju na temperaturi od cca 121°C.
04.1.0137.00 | ITS-19
Germicidna lampa otvorena, 30W
Šifra
04.1.4520.00
04.1.4521.00
Germicidna lampa za zrak u zatvorenom prostoru odnosno za sterilizaciju tekućina i držanje steriliziranih uređaja i materijala u sterilnom stanju. Osim toga, služi za sterilizaciju zraka u ventilacijskim i klimatizacijskim sustavima, za sterilizaciju zraka u radnim prostorima, za uništavanje virusa, bakterija i gljivica.

Tehničke karakteristike:
• napon: 230V ~ 50Hz
• gustoća: 0,2 0,4 W / m3

• tip germicidne cijevi: TUV 30 W, snaga: 30 W / kom
• ultraljubičasto zračenje: 11,2 W / kom, valna duljina: 253,7 nm
• gustoća radijusa: 100 m od udaljenosti od 10 µW / cm2 / kom
04.1.4520.00 | zidna
04.1.4521.00 | na stalku
PROLUX G ® K36W DO germicidna lampa s daljinskim upravljačem
Šifra
04.1.5512.00
Najučinkovitija metoda dezinfekcije je dezinfekcija zraka i površina. Ubija više od 99,7% virusa, bakterija i gljivica! Kako izravno UV-C svjetlo jako šteti živom organizmu, strogo je zabranjeno boraviti u prostoriji za vrijeme rada lampe!
Tehničke karakteristike:
• Dizajn: zidni

• Fluorescentna lampa: Philips 36W UV-C fluorescentna svjetiljka valne duljine 253,07 nm
• Vijek trajanja fluorescentne svjetiljke: cca. 18.000 sati
• Veličina: 1020 x 85 mm, težina: 2,8 kg
Germicidna lampa, zidna 30 W
Šifra
04.1.0828.00
PROLUX G ® 30WA zatvorena germicidna lampa, uključen ventilator 14,8 dB
04.1.5513.00
04.1.5514.00
Najučinkovitija metoda dezinfekcije je dezinfekcija zraka. Ubija više od 99,7% virusa, bakterija i gljivica! Fuorescentna svjetiljka je u zatvorenom kućištu i sterilizira samo usisni zrak. Vrlo je praktična jer se može koristiti čak i u prisutnosti ljudi u prostoriji.Deaktivira i uništava mikroorganizme u zraku (viruse, bakterije i gljivice). Može raditi kontinuirano. Ne izlučuje ozon. Potpuna zaštita od UV-C zračenja, može se koristiti u prisutnosti ljudi.
Tehničke karakteristike:


• fluorescentna lampa: Philips 30W UV-C fluorescentna svjetiljka valne duljine 253,07 nm
• Vijek trajanja fluorescentne svjetiljke: cca. 18.000 sati
• Zapremina zraka za dezinfekciju: 60 m³ / h
• Veličina: 1020 x 85 mm, težina: 2,8 kg
04.1.5513.00 | zidna
04.1.5514.00 | na stalku
Germicidna lampa, stolna
Šifra
04.1.2940.00
04.1.3556.00

Prikladna za čuvanje instrumenata kako bi se održali sterilnima. Kućište je izrađeno od obojanog nehrđajućeg čelika, a unutarnji dio od sjajnog nehrđajućeg čelika koji reflektira svjetlost. Unutarnja rešetka omogućuje da instrumenti budu izdignuti i od reflektirajuće površine, čime se postiže ravnomjerna radijacija obje površine te se povećava djelotvornost UV germicidnog učinka. Napon: 230 V - 50/60 Hz. Dimenzije lampe od 8 W: 38×20×17 cm. Dimenzije lampe od 15 W: 50×24×20 cm.
04.1.2940.00 | 8W
04.1.3556.00 | 15W
Pogodna je za sterilizaciju zraka, pomaže u očuvanju sterilnosti prethodno sterilizirane opreme i materijala; pogodna za sterilizaciju u dovodima zraka, te sustavima za ventilaciju i klimatizaciju, čime se omogućuje sterilizacija radnih prostora. Dimenzije: 20×95×14 cm. Napon: 230 V~50Hz. TUV 30 W snaga: 30W/kom. Ultraljubi často zračenje: 11,2 W/kom, valna duljina 253,7 nm, gustoća zrake s udaljenosti od 1 m: 100 mW/cm2 / kom. Promjer: 2,6 cm. Broj germicidnih lampi potrebnih za 99-postotnu sterilizaciju prostorije s pretpostavkom da je visina prostorije 3-4 m.

Šifra
04.1.4514.00
04.1.4515.00
04.1.4512.00
04.1.4513.00
04.1.4510.00
04.1.4511.00
04.1.4516.00
04.1.4517.00
04.1.4514.00 | GARA 30WO / zidni tip
04.1.4515.00 | GARA 30WO / mobilni
04.1.4512.00 | GARA 30WO/C / zidni tip
04.1.4513.00 | GARA 30WO/CZ / zidni tip
04.1.4510.00 | GARA 30WU / zidni tip
04.1.4511.00 | GARA 30 WU / mobilni
04.1.4516.00 | GARA 2×30WK / zidni tip
04.1.4517.00 | GARA 2×30WK / mobilni



WU
jednocijevni, zatvoren, s ventilacijom WO
Jednocijevni, otvoreni, bez ventilacije
Uređaji s automatskim upravljanjem dizajnirani su za uništavanje mikroorganizama u zraku. Kombinirana i zatvorena verzija izrađena je od nehrđajućeg čelika. Simbol „/M“ označuje mobilnu verziju, a simbol „C/,CZ“ označuje verziju bez sata koja je prikladna za centralno upravljanje. Kombinirani uređaj za uništavanje mikroorganizama najbolje je rješenje za dezinficiranje prostorija. Prikladno postavljanje vremena izlaganja omogućuje pogodno kombiniranje izravne i neizravne iradijacije uzimajući u obzir osobe koje se nalaze u prostoriji. Izravna radijacija zraka cjelokupne prostorije najučinkovitiji je način sterilizacije zraka. Obuhvatit će cjelokupni zrak i uništiti mikrobe i na zidovima i na podu. Praktična upo-
Tehnički podaci
WO / C
Jednocijevni, otvoreni, bez ventilacije, zidni tip
treba izravne radijacije namijenjena je isključivo za prostorije u kojima nema ljudi. Neizravna radijacija označuje sterilizaciju zraka, i to ventilacijom zraka putem ugrađenog uništavača mikroorganizama odnosno horizontalnog zračenja gornjeg sloja zraka. Primjenom ove metode zrači se strop prostorije, a zahvaljujući izazvanom ili prirodnom protoku zraka postiže se sterilizacija cijele prostorije. Sterilizacija prostorija s niskim stropom nije najbolja, a raste i rizik obolijevanja osoba koje se nalaze u prostoriji.
Količina radijacije za cijevi s izbojem germicidnog učinka od 30 W je 50 mW/cm2 na udaljenosti od 1 m; napon: 230V/50 Hz; zaštita: IP20.

Dvocijevni, otvoren ili zatvoren, s ventilacijom
2×30 WK
Nominalna ulazna snaga 125 VA 75 VA 75 VA 75 VA
Težina 9 kg 5,5 kg 3 kg 2 kg
Količina sterilizir. zraka po satu 110 m3/sat 110 m3/sat - -
Dimenzije /cm/ 125×15×14 117×13×9 105×10,5×5 95×10,5×5
Cijev s izbojem germicidnog učinka 2×30 W 30 W 30 W 30 W
Broj programa 7+7 7 7 7
U tablici je prikazan broj uređaja potrebnih da bi se ostvarila 90% sterilnost prostora (Izlazna snaga uređaja za uništavanje mikroorganizama – 30 W, visina prostorije: 2,7 do 3,0 m).

Dispenzer za papirnate ručnike
Šifra
04.2.2120.00

Plastični dispenzer za složene papirnate ručnike. Kapacitet: 250 listova. Napravljen od posebne ABS plastike otporne na udarce; može se zaključati posebnim ključem. Dimenzije: VDŠ - 28x29x14 cm. Namijenjen za papire 04.2.5773.00, 04.2.2121.00, 04.2.5739.00.
Dispenzer za papirnate ručnike Pur-Zellin
04.2.1162.00
Dispenzer za papirnate ručnike Pur-Zellin

Dispenzer za toaletni papir Comfort
04.2.2411.00
Napravljen od posebne ABS plastike otporne na udarce; može se zaključati posebnim ključem. Kapacitet: rola papira fi 19 cm. Dimenzije: VDŠ38x22x15 cm.

Dispenzer za papirnate ručnike u roli
Od nehrđajućeg čelika. Kapacitet: rola papira promjera 20 cm, visine 25 cm. Može se zaključati posebnim ključem. Dimenzije: 21 x 37 x 22 cm. Namijenjen za papire 04.2.5811.00, 04.2.1357.00

Dispenzer za papirnate ručnike u roli M
Napravljen od posebne ABS plastike otporne na udarce; može se zaključati posebnim ključem. Kapacitet: rola papira fi 14 cm. Dimenzije: VDŠ - 33x18x18 cm. Namijenjen za papire 04.2.5811.00, 04.2.1357.00.

Dispenzer za ručnike i vate u roli Maizell
04.2.5787.00
Plastični dispenzer s »anti-slip« površina za stabilnu dispenziju. Služi za higijensko čuvanje i dispenziju. Namijenjen za vatu u roli 10.0.5803.00.
Maizell celulozna vata u roli 2x500 komada
10.0.5803.00
Primjenjuje se u obliku upijajućih jastučića ili tampona na vanjske rane i manje ozlijede, čišćenje kože prije injekcija i razne laboratorijske potrebe. Perforirana rola : 4x5 cm. Izbjeljeno prema standardu DIN EN 19310 DAB. Moguća sterilizacija na temperaturi od 121 ° C ili etilen oksidom.

Papirnati ručnici

Papirnati ručnici | 3000 komada
04.2.5773.00 | Dim: 25×23 cm; snježno bijela
Papirnati ručnici | 5000 komada
04.2.2121.00 | Dim.: 25×23 cm; siva boja
Papirnati ručnici u roli M
04.2.1357.00

Perforirani papir Dimenzije: 14 x 20 cm, 70 m dužina. Bijela.


Ingo-man dispenzer za dezinfekcijsko sredstvo
04.2.1526.00
04.2.2259.00
Visoki higijenski standardi. Pumpica se može odvojiti i staviti u autoklav. Spremnik nije uključen.
04.2.1526.00 | 0,5l
04.2.2259.00 |1,0l

SM 2 Universal dispenzer
Prikladan za tekuće sapune, dezinfekcijska sredstva i proizvode za njegu ruku; brzo i točno doziranje. Podesivo doziranje: 1-3 ml. Laka i brza zamjena spremnika. Mehanizam s pumpom se lako mijenja. Čvrsta plastična konstrukcija koja ne hrđa. Kapacitet: 450, 500 ili 1000 ml. Spremnik nije uključen.

Beskontaktni dispenzer za dezinficijens ili sapun 1100ml
Uređaj je digitalno kontroliran infracrvenim senzorom za detekciju pokreta ruku te napajan s četiri AA baterije. Postavljanjem ruke ispod infracrvenog senzora automatski se dijeli doza tekućine za sanitaciju ili sapun. Bez-kontaktni rad sprječava prijenos patogena kontaktom. Nisko energetski rad omogućava prolongirano korištenje bez zamjene baterije. Idealan odabir za kućanstva, hotele, restorane i slično. Montira se na zid. Baterije: 4 x DC 1.5 V AA.
Samostojeći
metalni stalak za SSGD dozator

Dispenzer za dezinfekcijsko sredstvo Dermados S, plastični
04.2.1666.00
04.2.4340.00
Precizno doziranje, površina otporna na alkohol. Pumpica se može lako odvojiti i staviti u autoklav.
04.2.1666.00 | 0,5l
04.2.4340.00 | 1,0l

Dispenzer za sapun
04.2.4399.00
04.2.4386.00
Od nehrđajućeg čelika s unutarnjim punjivim plastičnim spremnikom. Prikaz razine sadržaja. Ispoliran, može se otvoriti i zatvoriti posebnim sustavom za zaključavanje.


04.2.4399.00 | 0,4l
04.2.4386.00 | 0,9l
Dispenzer za dezinfekcijsko sredstvo i sapun s ručicom za lakat | zapremina 1l

Dispenzer za dezinfekcijsko sredstvo i sapun s ručicom za lakat izrađen je od čvrste ABS plastike što ga čini izdržljivim i otpornim na udarce. Spremnik je zapremine 1 litre a oslobađa se otključavanjem donjeg dijela dispenzera priloženim ključem.

Samostojeći metalni stalak za dozator na lakat

Dekontaminirajuća podloga
Dekontaminirajuća podloga, plava, dimenzije 60x115 cm, 30 listova.

Jednokratni plastični spremnici otporni na ubode i porezotine za odlaganje igala i infektivnog otpada. Sprječavaju curenje opasnog otpada iz spremnika, te su veoma izdržljivi na udarce. Svi imaju privremene i trajne poklopce, široke otvore za odlaganje te ureze za skidanje igala.
Šifra Vel
DAILY LINE -5L 5l
DAILY LINE -6I 6l

LINE

Šifra Vel
DISPO LINE-0,5I 0,5l
DISPO LINE-0,7I 0,7l
DISPO LINE-1I 1l
DISPO LINE-1,5 I 1,5l
DISPO LINE-2I 2l
DISPO LINE-2,5I 2,5l


PBS LINE -7I 7l PBS LINE -12I 12l









Kolica za čišćenje i kante za otpad
Kolica za čišćenje, Roll-Mop
Šifra Opis
04.2.4383.00 1 kanta






Kolica za čišćenje KOMBI JOOKY III
04.2.1441.00 2 kante Šifra 04.2.4073.00
Kromirano postolje na 4 kotačića, s košaricom za deterdžent, cjedilom i plastičnom kantom od 17 l .

Bez drške i krpe za pod!

Kanta za otpad od nehrđajućeg čelika
Šifra Opis
FAZZ-02.411.00 5 l
FAZZ-02.425.00 14 l
FAZZ-02.424.00 20 l


2 kante od 13 litara i dvije kante od 6 litara. 3 plastične posude od 6 litara. Držač vrećice za smeće; cjedilo. Dimenzije: 103 × 60 × 112 cm.
Bez drške i krpe za pod!

Pamučna krpa za pod, 40 cm
Aluminijska drška
Šifra 04.2.1447.00
Šifra 04.2.1827.00

Elektrokirurški uređaj DIATROM 50 W
06.5.1945.00

Monopolarni elektrokirurški uređaj s visokofrekventnim rezanjem i koagulacijom za manje operacije. Načini rada: čisti rez, rez/koagulacija, koagulacija. Širok raspon primjena: dermatološka, kozmetička, dentalna i oralna kirurgija, plastična, estetska, veterinarska kirurgija.
Tehničke karakteristike:
• Snaga: 40-50 W
• Radna frekvencija: 600 kHz
• Dimenzije: 190x239x85 mm
• Težina: 2,5 kg
Elektrokirurški uređaj DIATROM 200
Šifra
06.5.2492.00
Dijatermokoagulator za monopolarne ili bipolarne precizne kirurške zahvate u visokoprofesionalnom okruženju. Namijenjen za prikupljanje uzoraka tijekom biopsije, mikrokirurgiji i preciznim zahvatima u dermatološkoj kirurgiji. Omogućava kirurški minimalno invazivno liječenje resekcijom, evaporacijom i koagulacijom.
Tehničke karakteristike:
• Snaga: 200 W
• Radna frekvencija: 600 kHz

• Dimenzije: 360x260x150 mm
• Težina: 8 kg
Elektrokirurški uređaj DIATROM 200 TOUCH SCREEN
Šifra FAZZ-10200.00T
Dijatermokoagulator za monopolarne ili bipolarne precizne kirurške zahvate u visokoprofesionalnom okruženju. Namijenjen za prikupljanje uzoraka tijekom biopsije, mikrokirurgiji i preciznim zahvatima u dermatološkoj kirurgiji. Omogućava kirurški minimalno invazivno liječenje resekcijom, evaporacijom i koagulacijom. Upravljanje touch screenom.
Tehničke karakteristike:
• Snaga: 200 W
• Radna frekvencija: 360 kHz

Elektrokirurški uređaj DIATROM 80 W | 120 W | 160 W
Šifra
06.5.2624.00
06.5.3134.00
06.5.2334.00

Monopolarni elektrokirurški uređaj s visokofrekventnim rezanjem i koagulacijom za manje operacije. Mogućnost odabira funkcija uređaja: čisti rez (CUT), rez uz koagulaciju (BLEND), površinska koagulacija (COAG FORCED), duboka koagulacija bez karbonizacije (COAG SOFT) te bipolarna koagulacija (BIPOLAR) uz posebni adapter.
Tehničke karakteristike:
• Snaga: 80 - 120 W
• Radna frekvencija: 600 kHz
• Dimenzije: 370x320x140 mm
• Težina: 6 kg
• Dimenzije: 254x288x104 mm
• Težina: 5-7 kg
Elektrokirurški uređaj DIATROM Flash 200 F
Šifra
06.5.5630.00
Namijenjen za upotrebu u mikrokirurgiji, monopolarnoj i bipolarnoj kirurgiji i u dijatermijskim postupcima, prikladan za obavljanje kirurških zahvata koji zahtijevaju visoku razinu preciznosti. Mogućnost odabira vremena djelovanja struje pomoću ručnog ili nožnog prekidača: od tisućinki sekunde do čitavog trajanja operacije. 9 različitih programa.
Tehničke karakteristike:
• Snaga: 200 W
• Radna frekvencija: 600 kHz

• Dimenzije: 360x265x150 cm
• Težina: 8 kg

Svestrana monopolarna i bipolarna elektrokirurška jedinica za profesionalnu kirurgiju. Dvostruka aktivnost: radi u monopolarnom načinu rada: dva izlaza poprečno / dva izlaza koagulacije. Automatsko pokretanje i zaustavljanje mogu se zasebno aktivirati.
Tehničke karakteristike:
• Snaga: 200 W
• Radna frekvencija: 425 kHz
• Dimenzije: 470x400x150 mm
• Težina: 17,5 kg
Jednokratne elektrode za koagulaciju
06.5.1751.01
06.5.1751.02
06.5.1751.03

Kabel za gumeni jastučić za neutralne elektrode
Komplet višekratnih elektroda | 10 komada
06.5.0006.00
06.5.2625.00
Elektrokoagulator SMT BMM PF
Bipolarna hvatalica
Držači elektroda
Adapter i kabel za bipolarnu hvatalicu
Snažan, moderan, pouzdan

SMT BMM PF je jednostavan za rukovanje i pouzdan elektrokirurški uređaj kompaktnog i ergonomskog dizajna. Njegova maksimalna snaga od 400 W, razni izlazni načini rada i jednostavno rukovanje čine ga snažnim uređajem za širok raspon medicinskih primjena. Ovaj elektrokoagulator kompaktnog dizajna nudi do 15 načina rada za monopolarni i bipolarni izlaz, dobro organiziranu kontrolnu ploču, indikator kontakta s pacijentovom pločom izravno na priključku i 12 korisničkih programa. Ovaj uređaj podržava načine rada za minimalno invazivnu kirurgiju, kao što su bipolarni plazma rez SAL ili automatska bipolarna koagulacija SEAL.
Tehničke karakteristike:
• Napajanje: 230 V / 50 Hz
• Dimenzije: 351 x 387 x 103 mm
• Težina: 6,7 kg
• Sigurnosna klasa: II
• Maksimalna izlazna snaga: 400 W
• Radna frekvencija: 460 kHz
Slika je informativnog karaktera, uređaj dolazi bez postolja

Sterilni bipolarni elektrokauter za jednokratnu upotrebu, namijenjen za izvođenje manjih kirurških zahvata. Trajanje ugrađene baterije: 25 minuta rada.Radna temperatura: 1200 °C.
06.5.2161.00 | Elektrokauter
06.5.5438.00 | Elektrokauter ginek
06.5.2161.00
06.5.5438.00
Napajanje: Zamjenjiva baterija tipa AA. Precizna hvataljka. Nesterilan, bez nastavaka. Glave za elektrokauter za jednokratnu uporabu (06.5.5421.01 / .02/ .03) se zasebno kupuju.

Sterilni, za jednokratnu upotrebu.
06.5.5421.01 | Duljina: 30 mm
06.5.5421.02 | Duljina: 120 mm
06.5.5421.03 | Duljina: 30 mm
06.5.5421.02

06.5.5421.03

06.5.5421.01
Ionoderm iontoforeza, galvanizacija i tretman hiperhidroze

Uređaj Ionoderm proizvodi struje s terapeutskim djelovanjem, te je prikladan za galvanizaciju i iontoforezu. Dvije vrste kontinuirane struje omogućuju korištenje uređaja za galvanizaciju, terapeutsku iontoforezu i tretmane hiperhidroze. Omogućena je upotreba obje vrste struje, kontinuirane struje ili kvadratne struje na niskoj frekvenciji, koja je najvećim dijelom indicirana za prijenos ljekovitih tvari. Uređajem upravlja mikroprocesor i ima 2 izlazna voda. 6 unaprijed postavljenih programa. Radi na temelju odabranih parametara ili unaprijed postavljenih programa. Ugrađen računalni program na engleskom, talijanskom i francuskom jeziku.
Tehničke karakteristike:
• Napajanje: 230 V/50 Hz
• Potrošnja: 40 VA
• Unutarnji osigurač: T 500mA
• Vrijeme tretmana: 1 do 60 min
• Dimenzije: 270 × 220 × 110 mm
• Težina: 1,4 kg

LTE350 LASER PLUS je kontrolni uređaj za lasersku diodu koja emitira monokromatsku lasersku svjetlost (blizu infracrvene svjetlosti) (905 nm). Uređajem elektronički upravlja mikroprocesor, a ima jedan izlaz. Uređaj nudi prethodno postavljene programe, a moguće je odabrati i različite parametre. Programi se automatski modificiraju ovisno o odabranoj snazi laserske sonde. Uređaj Laser Plus opremljen je sigurnosnim kontrolnim sustavom koji automatski isključuje zračenje u slučaju da je sonda pogrešno prislonjena ili uopće nije prislonjena. Uređaj je opremljen sondom s jednom diodom snage 30 W, ali se na njega mogu priključiti razne sonde, različitih snaga i s različitim brojem laserskih dioda.
Tehničke karakteristike:
• Napajanje 230 Vac / 50 Hz
• Potrošnja: 22 VA
• Unutarnji osigurač: tip T 500 mA
• Izlazna frekvencija od 1 - 10000 Hz

Ionostim uređaj proizvodi dijadinamične struje koje ublažavaju bolne upale mišića, upale zglobova i perifernih živaca, te je također koristan u sportskoj medicini za brzo cijeljenje povreda i hematoma. Faradske struje za stimulaciju mišića. Kontinuirana struja (galvanska) koja se može proizvesti zasebno ili se može kombinirati s dijadinamičnom i faradskom strujom. TENS struja za analgetske tretmane. Uređajem u potpunosti upravlja mikroprocesor, ima dva izlaza. 40 unaprijed postavljenih programa. Uređaj radi na temelju odabranih parametara ili odabira unaprijed postavljenih programa. Ugrađen računalni program na engleskom, talijanskom i francuskom jeziku
Elastična traka za pozicioniranje elektroda
• Trajanje tretmana od 1 do 60 minuta
• Dimenzije: 270 × 220 × 110 mm
• Težina: 1,3 kg
Tehničke karakteristike:
• Napajanje: 230 V/50 Hz
• Potrošnja: 40 VA
• Unutarnji osigurač: T 500mA
• Izlazni napon:100 V DC
• Vrijeme tretmana: 1 do 60 min
• Razina zaštite: IP20
• Dimenzije: 270 × 220 × 110 mm
• Težina: 1,4 kg



Magnum XL PRO magnetoterapijski uređaj
Šifra
Profesionalni magnetoterapijski uređaj sa pulsnim nisko-frekventnim magnetskim poljem za biostimulaciju i regeneraciju poremećaja mišićno-koštanog sustava. Preporuča se za artrozu, osteoporozu, frakture i degeneraciju koštanog tkiva. Može spremiti 10 novih programa sa personaliziranim parametrima.
Tehničke karakteristike:
• Kanali: 2 kanala
• Prikaz: Veličina vidljivog područja 2,6"
• Frekvencija: 5-200 Hz
• Kontrola intenziteta sa fleksibilnim difuzorima:

200 Gaussa prosjek po kanalu; 400 ukupni prosjek
Gaussa (za 2 kanala)
• Radni ciklus: 5-50%
• Napajanje: Mrežna punjiva baterija (nije uključena)
• Dimenzije: 100x160x35 mm
• Težina: 280 g
Uređaj za elektrostimulaciju 2001+

Uređaj TENSEL s 9 programa stimulacije mišića + uređaj TENS s adapterom za priključenje na električnu mrežu. Indikacije: liječenje mišića, mjerenje stanja mišića, ublažavanje boli, iontoforeza. Posebna TENS -metoda liječenja denervacije. Frekvencija TENS -a: 1-200 Hz. Primjena TENS impulsa u liječenju kroničnih bolova, struja za selektivnu stimulaciju, liječenje paralitičnih ili poluparalitičnih mišića, liječenje inkontinencije miješanog tipa.


Uređaj za ultrazvučnu terapiju Ultron Home

Mogućnost kontinuirane i impulsne ultrazvučne terapije, ultrazvučna glava u dvije veličine (velika i mala). Prikladan za liječenje pod vodom, automatska kontrola kontakta, jasan prikaz parametara. Jednostavno korištenje pomoću upravljačke ploče prilagođene korisniku. Kompaktna veličina, jednostavno održavanje.
Tehničke karakteristike:
• Napajanje: električna mreža, 230 V, 50 Hz
• Frekvencija: 800 - 860 kHz
• Vrijeme liječenja: podesivo, od 0 do 30 min.
• Intenzitet ultrazvuka: impulsni - 0,1 - 3 W/cm2; kontinuirani - 0,1 - 2 W/cm2
• Površina ultrazvučne glave: velika - 4,2 cm2; mala - 1,77 cm2
• Dimenzije: 260×220×100 mm
• Težina: 3 kg
TENSEL 2006 profesionalni elektrostimulator

Dvokanalna terapija - istovremeno stimuliranje 2 grupe mišića. Uređaj TENSEL s 9 programa, stimulator mišića + uređaj TENS s adapterom za priključenje na električnu mrežu. Indikacije: liječenje mišića, mjerenje stanja mišića, ublažavanje boli, iontoforeza. Posebna TENS metoda liječenja denervacije. Frekvencija TENS -a: 1-200 Hz. Primjena TENS impulsa u liječenju kroničnih bolova, struja za selektivnu stimulaciju, liječenje paralitičnih ili poluparalitičnih mišića, liječenje inkontinencije miješanog tipa. Dolazi u plavoj/zelenoj boji upravljačke table.
Uređaj za ultrazvučnu terapiju Minisono Home
Kompaktan, lagan uređaj, isporučuje se u plastičnom kovčežiću. Prikladan za kućnu upotrebu. Frekvencija ultrazvuka: 1 W/cm2. Način rada: kontinuirani ili impulsni.
Za liječenje:
• istegnuća mišića,
• bolova u mišićima,
• intersticijalne upale,
• kronični artritis,
• neuritis,
• radikulitis,
• neuralgija,
• artroza,
• liječenje čireva i keloida,
• unošenje lijekova,
• lomovi,
• trizmus,
• lumbago

Dvokanalni TENS, masažer i stimulator
Šifra
LT3011A
Dvokanalni TENS, EMS i masažer sa 78 predefiniranih programa. Preglednog ekrana i jednostavan za upotrebu. Uređaj je vrlo lagan i prikladan za prenošenje s obzirom na težinu od 140 grama, uključujući baterije. Koristi 4 elektrode.
Tehničke karakteristike:
• Materijal: ABS
• Kanali: 2 kanala
• Napajanje: 4× AAA baterije

• Oblik vala: bifazni kvadratni puls
• Trajanje impulsa: 30-350 μs | Frekvencija pulsa: 1-290Hz
• Vrijeme terapije: 5 - 90 min | Intenzitet: Podesiv od 0 do 90mA (pri 1000 oma)
• Uvjeti rada: od 5 do 40°C; relativna vlažnost: 30 - 85%, atmosferski tlak: 700 - 1060 hpa
• Skladištenje: od -10 do 50°C; relativna vlažnost: 10 - 90%, atmosferski tlak: 700 - 1060 hpa
• Dimenzije: 117×60×25× (bez pojasa)
• Težina: 110 g (bez baterija) | 140 g (s baterijama)
Bežični T.E.N.S., EMS i masažni uređaj
Šifra
LT5018B
Kompaktan i lako prenosiv uređaj bežične tehnologije dizajniran za jednoručno korištenje. Upravljanje uređajem putem bežičnog kontrolera. 3-u-1 opcije rada uređajaT.E.N.S., EMS i Masažer uz 14 predefiniranih programa i odabir 60 nivoa inteziteta tretmana. Elektrode uređaja pokretane su punjivom litij-ionskom baterijom.
Tehničke karakteristike:
• Broj kanala: 1 kanal
• Modovi tretiranja: 3 moda
• Programi: TENS - 6 programa
• EMS - 5 programa
• MASAŽA - 3 programa
• Intenzitet: 60 razina odabira inteziteta
• Napajanje: Elektrode: punjiva 3,7V Litij-ionska baterija


• Daljinski: DC 3,0V 2xAAA baterije
• Zaslon: Veliki crni zaslon s bijelim prikazom, lako je čitljiv te je prilagođen korisniku za rukovanje
• Karakteristike: Prijenosan
• Diskretan
• Nevidljiv pri korištenju
Četverokanalni T.E.N.S. i EMS uređaj
RelieFit 4.0
Šifra
LT-3062D
Četverokanalni uređaj s 8 elektroda - veliko područje djelovanja. 4-u-1 opcije rada uređajaT.E.N.S., EMS, SPORT i FITNESS. M-coach sustav za jednostavno korištenje uz pomoć aplikacije na vašem Android ili iPhone uređaju. Intuitivan i pregledan LCD zaslon samog uređaja omogućava jednostavno korištenje. Ciljani tretmani.
Indikacije:

• Simptomatsko ublažavanje kronične boli koju je teško liječiti, akutne posttraumatske boli ili akutne boli nakon operacije
• Povećanje dotoka krvi u tretirano područje
• Opuštanje mišićnog spazma
• Stimulacija mišića neposredno nakon operacije s ciljem sprječavanja venske tromboze
• Sprječavanje ili usporavanje atrofije prouzročene smanjenom upotrebom mišića
• Re-edukacija mišića
• Održavanje ili povećanje pokretljivosti tijela

Šifra Opis
ET-02 2 para elektroda za TENS uređaje (LT3011, Premier plus, Medfit, MB410)
ET-03
TOW003537
KT-03
KT-04
KT-05
KT-06
KT-08
Elektroda za T.E.N.S. MB-400
Elektrode za TENS-ove NEM-100, HMB-1000 i HMB100
Kabel za T.E.N.S. DX6605d, 8038, DX6611 i 8050
Kabel za T.E.N.S. MB-400
Kabel za TENS-ove NEM-100, HMB-1000 i HMB100
Kabel za T.E.N.S. LT1041
Kabel za T.E.N.S. LT3011A
Šifra FO-GP1000
Physiolaser 1000 je profesionalni uređaj za lasersku terapiju. Sadrži glavne programe namijenjene ubrzanju oporavka upaljenog tkiva, regeneraciji stanica i poboljšanju mikrocirkulacije 30 programa: 23 programa: Zdravlje / rehabilitacija; 7 proograma: Tretmani ljepote / Fitness
Zdravlje / rehabilitacija:
• Artroza – Uganuće gležnja – Bol u koljenu – Edem uganuća gležnja – Meniskopatija –Osteoartritis koljena – Ahilov tendinitis – Bol u prstima – Miofascijalna bol u ramenu – Bol u zglobu ramena – Epikondilitis – Smrznuto rame – Karpalni tunel – Kronična bol u leđima – Akutna bol u leđima – Bol u leđima s radikulopatije – Bol u vratu – Bol u vratu s radikulopatijama – Miofascijalna bol u vratu –Osteoartritis vrata – Temporomandibularna bol – Tendinopatije – Ozljede
Tretmani ljepote / Fitness:


• Bore – Akne – Dehidrirana koža – Pomlađivanje kože – Podizanje kože lica – Mimičke bore – Bore na vratu – Kuperoza – Teleangiektazije
• Strije na dojkama – Edematozni celulit na bedrima, bokovima i stražnjici – Fibrozni celulit na bedrima, bokovima i stražnjici – Masne naslage i celulit na velikim dijelovima tijela – Strije – Uklanjanje dlačica –Ožiljci – Lokalizirani limfni zastoj
06.1.5606.00
Prirodno liječenje, neinvazivno liječenje, bez nuspojava, bez unakrsnih infekcija. Ublažava grčeve mišića, ozljede mekih tkiva, sportske ozljede i uganuće, ozljede atletskog sustava, reumatoidni artritis. Punjivo za kontinuirani rad od 4 sata. Mali, ergonomski dizajn koji je jednostavan za držanje i prijenos. Pogodno za profesionalnu i osobnu upotrebu. Jednostavan za rukovanje. Savršena kombinacija 810nm & 650nm.
Tehničke specifikacije:
• Laserske valne duljine 810nm i 650nm

• Terminalni laserski izlaz 12 laserskih zraka s 650 nm; 1 laserska zraka s 810 nm,
• Maksimalna snaga: 5mW±20% 150mW ±20%
• Vrijeme korištenja: 4-5 sati
• Materijal leće: Kaljeno staklo
• Kapacitet baterije: Ugrađena litijska baterija 1500mAh

SwiSto3 set za iontoforezu za liječenje hiperhidroze
Šifra
06.1.5588.00
Iontoforeza je dokazna i učinkovita, dugoročno jeftinija, te sigurna terapija hiperhidroze. U usporedbi s injekcijama ili operativnim zahvatima, iontoforeza je bezbolna, i za razliku od lijekova ne izaziva nuspojave. SwiSto3 uređaj pruža mogućnost terapije kontinuiranom ili pulsnom strujom za liječenje znojenja na prostoru ruku, nogu i pazuha.
Tehničke karakteristike:
• Automatsko isključivanje nakon 2 minute neaktivnosti
• Potrošnja 1.5 W
• Dimenzije: 110 x 84 x 120 mm
• Podesiva izlazna struja 1-25 mA DC/+0/-3
• Tip struje: kontinuirana ili pulsna
• Napajanje pomoću punjive Li-ion baterije
• Kontinuirani rad




Uređaj za terapiju udarnim valovima | OCE-ESWT
Šifra
Vantjelesni udarni valovi su u osnovi akustični impulsi generirani izvan tijela, ali mogu biti fokusirani unutar njega. Ti su valovi karakterizirani velikim pozitivnim pritiskom (do 100 MPa) i malim negativnim (5-10 MPa). Specifični su po brzom usponu vala i kratkom trajanju (u milisekundama). Ovom terapijskom metodom liječimo kroničnu bol u ramenima, leđima, petama i laktovima.
Tehničke karakteristike:
• 7 ” zaslon osjetljiv na dodir u boji
• Energija: 10 - 185 mJ
• Frekvencija: 1-22 Hz
• Načini rada: kontinuirani / 4/8/12 poteza

Medicinski uređaj za ultrazvučnu fizioterapiju | OCE-ETUS-001
06.1.5607.00 Šifra
06.1.5608.00
Terapija ultrazvukom, tj. ultrazvuk zbog svog dvostrukog djelovanja, mehaničkog i toplotnog, predstavlja veoma efikasnu vrstu fizikalne terapije u terapiji brojnih patoloških stanja nervnog i koštano-mišićnog sistema. Terapija ultrazvukom poboljšava mikrocirkulaciju, podstiče relaksaciju tkiva i ubrzava metabolizam.
Tehničke karakteristike:

• Broj unaprijed postavljenih programa: 7
• Dimenzije aplikatora: 6x12x15 mmVeličina: 290 x 240 x 130 mm
• Težina: 2,07 kg
Infuzijska pumpa, ARGUS A717V
Tehničke specifikacije:
• Monokromatski LCD prikaz, izbornik na hrvatskom jeziku.
• Doziranje u g, mg, µg, ng, IU, mmol (po: satu, minuti, kg, danu)
• Automatski izračun doze, TIVA
• Protok: 0.1 - 1200 ml/h
• Vremensko programiranje:
1 min - 99 h 59 min
• priključenje na mrežni napon 20V 50Hz i 12V
• ugrađeno akumulatorsko napajanje, 12V/Ni-Cd
Infuzijska pumpa, ARGUS 616S

• kapacitet ugrađenih akumulatora > 5 sati rada ili 9 sati mirovanja
• dimenzije: 190 x 160 x 130 mm
• težina: 2 kg

Tehničke specifikacije:
• Protok: 0.1-1500 ml/h
• Vremensko programiranje:
1 min - 99 h 59 min
• Mogućnost programiranja protoka, volumena i vremena (ml/h, ml, h.min)
• Načini rada: standard, kalkulacija doze. TIVA, TCI ('samo TCI model)
Bolusvolumen 0,1 - 50 ml
• Za štrcaljke 10, 20, 30 i 50/60 ml.
• Pohrana do 1000 posljednjih događaja
• Ugrađeno akumulatorsko napajanje
• Kapacitet ugrađenih akumulatora gh na 5ml/h
• Frekvencija ultrazvuka od 1 i 3 MHz
• Maksimalni intenzitet 3W/cm2
• Frekvencija 16Hz/48Hz/100Hz
• Impulsni i kontinuirani načini rada
• Faktor pulsnog opterećenja: 10-90%, korak 10%
• 7” zaslon osjetljiv na dodir
• Ultrazvučna glava 5 cm2
• Vodonepropusni faktor ultrazvučne glave
• Dimenzija: 290×140×130 mm (uređaj)
• Težina: 4 kg
Sunfusion infuzijske pumpe
Semi-1, Erch-3 i Anim-5
Ključne značajke:
• Plug-in i modularni dizajn, omogućuje brzo sastavljanje, kombiniranje i jednostavno rukovanje.
• Jednostavna instalacija i demontaža zahvaljujući neovisnoj ručki - uređaj se brzo i jednostavno postavlja i uklanja.
• 3,5-inčni zaslon osjetljiv na dodir i tipkovnica za slobodan izbor načina upravljanja.
• Kompatibilnost sa štrcaljkama različitih zapremina: 2 ml, 5 ml, 10 ml, 20 ml, 30 ml, 50 ml i 60 ml.
• Mogućnost promjene brzine infuzije bez pauziranja odnosno prekida rada uređaja.
Semi-1: Osnovni model s plavim LCD zaslonom, bez Wi-Fi modula.
• Inteligentni alarmni sustav daje vizualna i zvučna upozorenja s dinamičnim uputama koje pomažu u pravodobnom rješavanju problema.
• Kompenzacija protoka za izbjegavanje pogrešaka.
• Redoviti podsjetnici za održavanje osiguravaju dugoročnu sigurnost i točnost uređaja.
• PBT kućište visoke kvalitete otporno je na koroziju i čini medicinsku dezinfekciju i čišćenje jednostavnima a samom uređaju osigurava dugotrajnost i pouzdanost
• Opcija sa i bez štrcaljke (perfuzor)

Erch-3: Napredni model s Wi-Fi modulom i kompatibilnošću s više dok stanica.

Anim-5: Premium model s kolor LCD zaslonom i maksimalnim mogućnostima povezivanja.


Sustav za kompresorsku terapiju - Advance (Limfna drenaža)
Šifra
LTM560
Kompresorska terapija za limfnu drenažu osim u kozmetičke svrhe anticelulitnih tretmana namjenja je osobama s limfedemom kako bi u udobnosti vlastitoga doma samostalno mogli obavljati tretman masaže protiv oticanja i bolova. Uređaj pruža iznimno ugodan osjećaj za vrijeme tretamana. Funkcionira tako da pumpa upuhuje te ispuhuje zrak u komore rukava, nogavice ili pojasa za trbuh prilikom čega stišće i masira pogođeno područje pokretom "mužnje" i na taj način potiče rad limfnih čvorova koji nakon toga otpuštaju nakupljenu vodu i otok potpuno splašnjava.
Tehničke karakteristike:
• Napajanje: 220V / 50Hz

• Pritisak: 20-250 mmHg
• Izlaz zraka: prilagodljiv
• Vrijeme ciklusa: 10-20-30 minuta
• Kabel za napajanje: 1,9 m
• Broj komora: 4
• Dimenzije i težina: 60 (d) x 170 (š) x 130 (v) mm; 2,6 Kg
LTM563-S 4-dijelni rukav sa cijevima S/M
LTM563-L 4-dijelni rukav sa cijevima L/XL
LTM566-S 4-dijelna nogavica sa cijevima S/M
LTM566-L 4-dijelna nogavica sa cijevima L/XL
LTM566-XXL 4-dijelna nogavica sa cijevima XXL
LTM566-3XL 4-dijelna nogavica sa cijevima XXXL
LTM569-S 4-dijelni pojas za trbuh sa cijevima S/M
LTM569-L 4-dijelni pojas za trbuh sa cijevima L/XL
LTM570 Cijev sa 4 izlaza za rukav i nogavicu
LTM571 Dvostruka cijev sa 4 izlaza za rukav i nogavicu
LTM572 Cijev sa 4 izlaza za pojas za trbuh
LTM568 Produžetak za nogavicu s cijevima
LTR590 4 adaptera u boji za cijevi







CryoIQ® - kriokirurški uređaji razvijeni su korištenjem inovativnih tehnologija u svrhu poboljšanja kvalitete kriokirurških postupaka na koži. Uređaji su pristupačni, sigurni i učinkoviti a koriste se za tretmane kožnih promjena u općoj medicini, dermatologiji, pedijatriji, ginekologiji, podijatriji, urologiji, estetskoj medicini i veterini. CryoIQ® su napredni, prijenosni, kompaktni kriokirurški uređaji koji precizno isporučuju sprej N₂O na kožne lezije, sa konstantnom temperaturom smrzavanja od -89°C / -128°F, te sa tlakom smrzavanja od 50 bara (725 psi), bez potrebe za anestetikom. Linija proizvoda CryoIQ sastoji se od dva različita kriokirurška uređaja. Oba instrumenta nude tekuće raspršivanje spreja ili kontaktno zamrzavanje. Uređaji se mogu nabaviti u obliku različitih setova koji sadrže različite kombinacije nastavaka. Također postoji i mogućnost nabave različitih pojedinačnih nastavaka. Uređaji koriste zamjenjive uloške sa N₂O.

• 1 nastavak za smrzavanje sprejem, promjer Ø 1-6 mm
• 1 plinsko punjenje N₂O od 25 grama
• 1 kartica - limitator površine smrzavanja
• 1 kofer za uređaj
• 1 korisnički priručnik - uputstva
Šifra Opis
CIQ-DAP-DST Nastavak za zamrzavanje - sprej, Ø1-6 mm
CIQ-DAP-T/C1 Nastavak za kontaktno zamrzavanje Ø1 mm
CIQ-DAP-T/C3 Nastavak za kontaktno zamrzavanje Ø3 mm
CIQ-DAP-T/C5 Nastavak za kontaktno zamrzavanje Ø5 mm
CIQ-DAP-T/C1-5 SET nastavaka za kontaktno zamrzavanje, Ø1, Ø3, Ø5 mm
CIQ-DA-C Plastična kutija za CRYO IQ DERM set







IQ PRO set:
• 1 standardni nastavak 60 μm, duž.=10 mm, smrzavanje sprejem Ø1-6 mm
• 1 dermatološki nastavak D2, dužine=22 mm, smrzavanje sprejem Ø7-18 mm
• 1 tijelo aplikatora sa aktivatorom plina
• 1 plinsko punjenje N₂O od 25 grama
• 1 kartica - limitator površine smrzavanja
• 1 kofer za uređaj
• 1 korisnički priručnik – uputstva
Nastavci za Cryo IQ PRO set - smrzavanje sprejem:
Šifra Opis
CIQ-PA-D1
CIQ-PA-D2
CIQ-PA-D3
CIQ-PA-D1-3
Dermatološki nastavak 60 μm, D=22 mm, smrzavanje -sprej , Ø1-6 mm
Dermatološki nastavak 80 μm, D=22 mm, smrzavanje-sprej, Ø7-18 mm
Dermatološki nastavak 100 μm, D=22 mm, smrzavamke-sprej, Ø9-22 mm
Dermatološki set PRO sa 3 nastavka (D1, D2, D3)
Nastavci za Cryo IQ PRO set - kontaktno smrzavanje:
Šifra Opis
CIQ-PA-C1 Nastavak za kontaktno smrzavanje Ø1 mm
CIQ-PA-C3 Nastavak za kontaktno smrzavanje Ø3 mm
CIQ-PA-C5 Nastavak za kontaktno smrzavanje Ø5 mm
CIQ-PA-C7 Nastavak za kontaktno smrzavanje Ø7 mm
CIQ-PA-C1-5 Set za kontaktno smrzavanje PRO sa 3 nastavka(C1, C3, C5)
Specijalni nastavci:
Šifra Opis
CIQ-PA-A45 Savinuti nastavak 45°, D=8 cm, smrzavanje -sprej, Ø 7-18 mm
CIQ-PA-L13 Dugi nastavak 100 μm, D=130 mm, smrzavanje – sprej Ø 9-22 mm








CIQ-PA-L13/5 Ginekološki nastavak 100 μm, savinuti 5°, D=130 mm, smrzavanje-sprej Ø9-22 mm

Šifra Opis
CIQ-G-VN25
Uložak od 25 grama s ventilom
Punjenje N2O 25 g, 1 kom. sa ventilom, za CryoIQ® DERM, DERM plus, PRO
CIQ-G-VN25x4 Punjenje N2O 25 g, 4 kom. sa ventilom, za CryoIQ® DERM, DERM plus, PRO


Sustav za krioterapiju CORTEX
CryoPro Maxi i Mini
Šifra
CX-CP-MAXI
CX-CP-MNI
Siguran, jednostavan za upotrebu i pouzdan. Visoka efikasnost tretmana pri -196°C putem kontaktnog smrzavanja ili spreja. Široka primjena uz relativno nisku cijenu po tretmanu. Namijenjeni su ustanovama s učestalom primjenom krioterapije.
U ponudi su dvije veličine:
• CORTEX CryoPro Maxi 0.5 l – 20 do 24 sata statičkog kapaciteta.
• CORTEX CryoPro Mini 0.35 l – 12 do 14 sati statičkog kapaciteta.

CRYOALFA aplikator tekućeg dušika
Šifra
CY CRYOA8
Visokokvalitetni kriokirurški instrument za tretiranje većine indikacija kožnih lezija sa N2O (precizna destrukcija).
Tehničke karakteristike:
• Tretiranje se vrši konstantnom radnom temperaturom pri -89°C tekućeg dušika N2O (patentirano) i brzinom smrzavanja oko 100K/min
• Zatvoren sistem,bez gubitka dušika
• Olovka dizajn hvatišta male veličine omogućuje jednostavnu i preciznu aplikaciju, prijenosan lagane težine, prikladan i za džep kute
• Opcija – različiti nastavci za multiterapeutske aplikacije
Izmjenjive patrone – izbor 16 g ( 20-30 aplikacija) ili 25 g (30-40 aplikacija)
CY CRYOA8B | Aplikator s patronom 16 g (komplet)
CY CRYOREF16LUX | Patrona 16 g
CY CRYOREF25LUX | Patrona 25 g


PATRONA za CryoAlfa aplikator tekućim dušikom, 16 ili 25 g
Šifra
CY CRYOREF
CY CRYOREF25
Patrone za CryoAlfa aplikator dostupne su u dvije gramaže, 16 i 25 g. Zatvoreni sistem za upotrebu s CryoAlfa aplikatorom.
CY CRYOREF | Patrona 16 g
CY CRYOREF25 | Patrona 25 g


Infracrveno zračenje ima raspon od 780 - 1400 nm te stvara toplinu koja se prenosi na ljudsko tijelo, ova svjetiljka namijenjena je samo za zračenje ljudskog tijela. Opskrba krvlju se povećava u zračenom području i povećava se brzina metabolizma u grijanom području. Infracrveno zračenje potiče tijelo na liječenje, stoga se primjenjuje na određenim područjima tijela. Kako toplina potiče na bolju cirkulaciju krvi i limfne tekućine, tako će se brže uklanjati metabolične i moguće toksične tvari te će se povećati opskrba krvi kisikom. Infracrveno svjetlo se može koristiti kao dodatan tretman u liječenju bolesti ušiju, nosa i grla te pomaže u održavanju ljepote i njege lica, naročito kod nečiste kože.
! Prije korištenja se savjetujte s obiteljskim liječnikom odgovara li ovaj tretman s medicinskog stajališta vama kao pacijentu.
Infracrvena svjetiljka 100/150W
Infracrvena svjetiljka 150W | SUN
Terapeutsko svjetlo za medicinske svrhe, dubinsko zagrijavanje tijela.
Tehničke karakteristike:
• potiče cirkulaciju i drenažu tkiva
• oslobađa mišićnu napetost
• smanjuje upale

• smanjuje bol bez lijekova kod artritisa, bursitisa, sinusitisa, teniskog lakta, neuralgiju, mišićne bolove, križobolju itd.
IR MM3000 - 100W
IR MM3001 - 150W
Zamjenske žarulje 100/150W
3000-1503 - 100W
3000-1505 - 150W


Svjetlosna terapija ili fototerapija sastoji se od izlaganja dnevnom svjetlu ili onom specifične valne duljine (polikromatsko polarizirano svjetlo, laseri, emitirajuće diode, fluorescentne lampe i sl). Najčešće se svjetlosna terapija koristi za ublažavanje raznih simptoma kožnih oboljenja, poput psorijaze, vitiliga, akni, raka kože i ostalih oboljenja.
Terapeutsko svjetlo za medicinske svrhe, dubinsko zagrijavanje tijela.
Tehničke karakteristike:
• potiče cirkulaciju i drenažu tkiva
• oslobađa mišićnu napetost
• smanjuje upale

• smanjuje bol bez lijekova kod artritisa, bursitisa, sinusitisa, teniskog lakta, neuralgiju, mišićne bolove, križobolju itd.
Zamjenska žarulja 150 W
Tehničke karakteristike:
• Stabilne i dugotrajne Philips posebne UV žarulje kao izvor svjetla
• Malen i lagan, pogodan za kućnu uporabu i kao prijenosni uređaj

• Odašilje svjetlo visokog intenziteta te polučuje brze rezultate
• Jednostavno korištenje
• Ugrađeni reflektor povećava djelotvorni utjecaj izloženosti svjetlu
• Posebno dizajnirani češalj olakšava korištenje uređaja na tjemenu
• Mogućnost doziranja i timer
• Ugrađena litij-ionska baterija
• S jednim punjenjem može izdržati 120 minuta rada
• OLED zaslon s velikim tipkama
Solna svjetiljka 2-3 kg

Unutrašnjost kristala obasjava žarulja i stvara ugodno svjetlo u rasponu od ružičasto-žutog do zagasito narančastoga. Slani kristali zagrijavanjem otpuštaju negativne ione koji poboljšavaju cjelokupno psihofizičko zdravlje. Pomaže kod astme, alergija, problema s dišnim putovima, umora i stresa . Težina kristala soli je 2 do 3 kg. Svaka lampa je unikatna i ne postoje 2 ista kristala soli.

Šifra Boja
16.0.6267.01 plava
16.0.6267.02 crvena
16.0.6267.03 bijela
Oblikovanje tijela, trening kod kuće, brzo i udobno. Vibracijsku platformu možete koristiti za mršavljenje, jačanje mišića i opuštanje. Uz Bluetooth MP3 player, to je preporučeni alat za smanjenje stresa, liječenje celulita i vježbanje. Mogu ga koristiti i starije osobe.
Tehničke karakteristike:
• poboljšava cirkulaciju
• poboljšava rad crijeva
• oblikuje lijepo bedro
• zateže stražnjicu
• oblikuje bokove i trbuh
• za liječenje reume
• za ramena
• za liječenje bolova u zglobovima i kostima
• Maksimalna nosivost: 150 kg
Pedale od kromiranog čelika sa šipkom i rotirajućim ručkama
Pedale za posttraumatsku rehabilitaciju i fizioterapiju namijenjene osobama s motoričkim poteškoćama ili hendikepom.
Tehničke karakteristike:
• štap s rotirajućim ručkama za vježbanje ruku
• dvostruki gumb za podešavanje intenziteta napora za ruke i noge
• Tehničke karakteristike:
• Dimenzije 54 x 42 x 24 cm
• Težina: 3,5 kg

Traka za vježbanje TheraBand
Šifra Boja
06.7.1496.00 Crna | Extra čvrsta
06.7.1993.00 Plava | Čvrsta
06.7.0789.00 Zelena | Srednje čvrsta
06.7.1021.00 Crvena | Labava
06.7.0788.00 Žuta | Veoma labava
Fleksibilne gumene trake za vježbanje. Pet različitih boja trake za pet razina čvrstoće. Što je traka čvršća, to je veći otpor tijekom vježbanja. Idealno pomagalo za fizioterapiju i trening. Duljina svake pojedine trake je 1,5 metara.

Lopte za vježbanje
Šifra Boja
06.7.5442.03 Crvena | 55 cm
06.7.5442.01 Zelena | 65 cm
06.7.5442.02 Plava | 75 cm
06.7.4019.00 Zelena | 65 cm
Sklopive pedale za rehabilitaciju s ekranom | crne


Namijenjene su vraćanju snage i jačanju mišića ruku i nogu. Idealne su za potrebe rehabilitacije, fiziklanu terapiju ili održavanje tonusa mišića. Lako podešavanje inteziteta otpora pomoću zakretnog regulatora na vrhu, te jednostavno podešavanje pedala za prihvat dlanova ili stopala. Uz uređaj dolazi i mali ekran na kojem možete vidjeti broj okretaja i vrijeme provedeno u vježbi. Uređaj se lako sklapa i rasklapa te jednostavno posprema.
Tehničke karakteristike:
• Dimenzije 40 x 50 x 23,5 cm
• Težina: 2,43 kg
• Maksimalna nosivost do 100 kg
Preklopne pedale | Bijele

Sklopive pedale za vježbe ili posttraumatsku i fizioterapijsku rehabilitaciju, pogodne za osobe s poteškoćama u kretanju. Opremljene su gumbom za podešavanje intenziteta vježbanja. Neklizajuće pedale od mekog plastičnog materijala.
Tehničke karakteristike:
• Dimenzije: (D) 44/27 x (Š) 38 x (V) 28/19 cm
Lopte na napuhavanje koje jačaju leđne mišiće, poboljšavaju držanje i sprječavaju bol u leđima, poboljšavaju gipkost, pokretljivost, snagu i izdržljivost. Prikladne za aktivno rastezanje, vježbanje i aerobik. Nosivosti do 150 kilograma.
• Težina: 2,5 kg
• Nosivost: 70 kg
• Boja: Bijela


Jež loptice za masažu
Šifra Boja
SUN-61006 Narančasta | 6 cm
SUN-61017 Ljubičasta | 7 cm
SUN-61023 Fan, dvobojna | 7 cm



Silikonske loptice za terapiju
Šifra POLY620-K

Jež loptice za vježbe šake
Šifra Boja JL8 Narančasta, mekša | 8,5 cm JL7 Zelena, tvrđa | 6,5 cm




Silikonske loptice za terapiju
Šifra Opis
70-505.01H Tvrda
70-505.01M Polutvrda
Komplet uključuje tri loptice različitog otpora u različitim bojama (meke, srednje i čvrste) za vaše specifične potrebe i personalizirani napredak. NatraCure loptice za vježbanje, pružit će prstima, rukama i podlakticama rehabilitaciju dijelove za koje vam je potrebna rehabilitacija.
Loptica za vježbanje šake - poliuretan
Šifra
70-505.01

Loptica od mekog spužvastog materijala (poliuretan). Loptica za vježbu šake iz naše ponude koristi se za područje ruku i dlana odnosno za vježbu šake.
Masažni pištolji
Masažni pištolj Vitammy BODY 5, 8 glava
Šifra Opis
TOW017479 crno-ljubičasti TOW017480 zeleno-zlatni
Masažom Vitammy Body 5 pištoljem poboljšava se mikrocirkulacija, smanjuje krutost mišića, ubrzava regeneracija i smanjuje kronična bol.
Tehničke karakteristike:
• Dimenzije: 230 x 210 x 60 mm
• Težina: 700 g
• Napon: 7,4 V
• Snaga: 20 W
• Baterija: Punjiva, litij-ionska
• Vrijeme rada: s u potpunosti punom baterijom od 3 do 5 sati rada




70-505.01S Mekana

Antistres loptica
Šifra A10130 Šifra 06.7.1410.00

Kolut za vježbanje, 10 cm

Prikladan za zagrijavanje, vježbanje ili upotrebu u terapijske svrhe.
Vitammy Body 8 masažni pištolj
Šifra TOW018559
Ovaj uređaj je izvrstan za sportaše prije treninga kako bi se učinkovitije zagrijali, te nakon svakog treninga za opuštanje i smanjenje napetosti mišićnog tkiva.
Tehničke karakteristike:
• Dimenzije: 184x245x55 mm
• Težina: 950 g
• Napon: 16,8 V
• Snaga: 20 W
• Baterija: Punjiva, litij-ionska
• Vrijeme rada: s u potpunosti punom baterijom od 12 do 24 sati rada






KVANT UM TIM
KINEZIOLOŠKA TRAKA
Upute za uporabu trebaju se pažljivo pročitati jer sadrže važne informacije o uporabi proizvoda. Molimo sačuvajte ove upute kako biste ih mogli prema potrebi ponovno pročitati.
KINEZIOLOŠKA TRAKA

Jednokratni medicinski proizvod namijenjen analgetskoj, ortopedskoj, neurološkoj, postoperativnoj i sportskoj fizioterapiji.
Smanjuje bol i napetost mišića te limfnu stagnaciju i limfedem. Bez lateksa. Proizvod nije sterilan.
Jednokratni medicinski proizvod namijenjen analgetskoj, ortopedskoj, neurološkoj, postoperativnoj i sportskoj fizioterapiji. Smanjuje bol i napetost mišića te limfnu stagnaciju i limfedem. Bez lateksa. Proizvod nije sterilan. Kinezio traka ublažava nelagodu i olakšava limfnu drenažu mikroskopskim podizanjem kože, te se time povećava intersticijalni prostor i omogućava smanjenje upale smanjujući pritisak na bolno mjesto, omogućavajući učinkovitiji protok krvi i limfne tekućine u i izvan ciljnog područja. Trake različitih boja izrađene su od materijala jednake elastičnosti i karakteristika.
Prednosti:
• Jednostavna primjena.
• Fleksibilna i udobna za nošenje.
• Može se nositi nekoliko dana.
ispravak nepravilnog položaja zglobova i njihovu stabilizaciju
• Može se nositi tijekom bavljenja sportovima na vodi te prilikom tuširanja i kupanja jer su vodootporne.
• Ne nadražuje kožu i lako se skida.
• Pomaže u uklanjanju boli.
• Ne sadrži kemikalije.
Odvijte traku i pomoću škara odrežite željenu duljinu i oblik. Kako biste spriječili guljenje rubova trake, odrežite im krajeve.
Pažljivo odvojite zaštitnu foliju s ljepila kako bi traka došla u kontakt sa što manjom površinom dlana.
Prije lijepljenja na kožu, pazite da ljepilo trake ne dođe u kontakt s nekom drugom površinom.
Vrijeme jednokratne uporabe trake na koži: do 7 dana, ovisno o načinu i mjestu primjene. Također, ako primijetite odvajanje i pomicanje rubova trake, uklonite proizvod s površine tijela. Kako biste produžili učinak jednokratne primjene, nakon skidanja trake stavite novi komad na isto mjesto.
SASTAV: Pamuk 97%, spandex, akrilno ljepilo.
VAŽNO: Proizvod trebate nanijeti na čistu suhu kožu te je preporučeno ukloniti dlake. Skidanje trake - polako skidajte traku suprotno od smjera rasta dlaka, dok niste potpuno skinuli proizvod. Lagano smočite površinu trake radi lakšeg uklanjanja.
Šifra Boja
STANDARDNA VELIČINA: 5 cm x 5 m.
Način primjene (slikovni prikaz): https://www.kvantum-tim.hr/news/index/view/?id=378
TOW002500 Svijetlo plava
TOW002504 Boja kože
UPOZORENJA:
TOW002508 Zelena
1. Proizvod je namijenjen za jednokratnu uporabu.
TOW002513 Crvena


Proizvod je namijenjen za samostalnu uporabu, međutim, savjetujemo korištenje trake prema preporukama liječnika ili fizioterap VRIJEME JEDNOKRATNE UPORABE TRAKE NA KOŽI: do 7 dana, ovisno o načinu i mjestu primjene. Također, ako primijetite odvajanje i pomicanje rubova trake, uklonite proizvod s površine tijela. Kako biste produžili učinak jednokratne primjene, nakon skidanja trake stavite novi komad na isto mjesto.


2. Za stavljanje trake potrebno je koristiti škare, stoga osobe koje ih ne znaju ili ne mogu koristiti ne smiju samostalno rezati traku.
3. Nemojte stavljati na otvorene rane i oštećenu ili nadraženu kožu.
TOW002515 Ružičasta
4. Ako je traka zaprljana, zamijenite je novom.
5. Korištenje kod djece je dopušteno samo pod nadzorom odrasle osobe.
TOW002517 Crna
6. Traka je za vanjsku uporabu. Ne smije se stavljati u usta ili na druga nenamijenjena mjesta.
TOW021432 Narančasta
7. Osobe alergične na akrilno ljepilo trebaju pažljivo koristiti trake.
8. Ako osjetite iritaciju ili nelagodu, odmah uklonite traku.
TOW021431 Žuta
9. Korištenu traku trebate smatrati potencijalno zaraznom i pravilno je odložiti.

10. Ako primijetite bilo kakve uznemirujuće simptome, odmah potražite medicinsku pomoć.



11.U slučaju ozbiljnih medicinskih incidenata, trebate obavijestiti proizvođača i Ured za registraciju lijekova, medicinskih uređaja i biocidnih proizvoda.
SKLADIŠTENJE:
Proizvod trebate čuvati u zatvorenom pakiranju na temperaturi 3-25 °C, na suhom mjestu. Držite dalje od izravne sunčeve svjetlosti. Čuvajte proizvod izvan dohvata male djece.
VELIČINA: širina 5 cm, duljina 5 m
KORIŠTENI SIMBOLI NA PAKIRANJU
Proizvođač
Datum proizvodnje
Nije sterilno
Ne sadrži lateks
Datum izdavanja Uputa za uporabu: 04.2022
Novamed.pl S.A.
street Dr. Stefana Kopcińskiego 62D, 90-032 Łódź POLAND
Izrezana kineziološka traka u roli Izrezana kineziološka traka u roli
Broj serije
Referentni broj
Medicinski proizvod
Tehničke karakteristike:
• Dimenzije: 5 x 25 cm
• Ukupna dužina 5 m
• Boja: Boja kože


Kvantum-tim d.o.o.
Voćarska ulica 6A 10437 Rakitje CROATIA
T: +3851 3637 453
E: kvantum-tim@kvantum-tim.hr
UM TIM
Changzhou DL Medical & Health Equipment Co., Ltd No. 528, Building A6, 88 Changhong Rd. Hutang Town Wujin District, Changzhou, Jiangsu, China
Riomavix S.L.
Tehničke karakteristike:
Calle de Almansa 55, 1D, Madrid 28039 Spain
• Dimenzije: 5 x 25 cm
• Ukupna dužina 5 m
• Boja: Crna i plava




Unaprijed profesionalno izrezane kineziološke trake prirodni su oblik pomoći kod tretiranja bolova u vratu, leđima, koljenu ili ruci, pogodne za nošenje kroz duži period vremena. Uz svako pakirnje unaprijed profesionalno pripremljenih i izrezanih kinezioloških traka dolaze jednostavne upute kako ih aplicirati što omogućava njihovu laganu primjenu i u udobnosti vašeg doma. Pravilno
SET ISTIH OBLIKA | 4 komada
Oblik traka: I
Šifra
GSPKTPP-001-pl
GSPKTPP-001-be
GSPKTPP-001-cr
Tehničke karakteristike:
• Dimenzije: 5 x 25 cm
• Boje: Plava, bež i crna
• 97% pamuk i 3% elastin





SET ISTIH OBLIKA | 4 komada
Oblik traka: X
Šifra
GSPKTPP-003-pl
GSPKTPP-003-be
GSPKTPP-003-cr
Tehničke karakteristike:
• Dimenzije: 5 x 10 cm
• Boje: Plava, bež i crna
• 97% pamuk i 3% elastin








Šifra
GSPKTPP-005-pl
GSPKTPP-005-be
GSPKTPP-005-cr
Oblik traka:
• 1 x X oblik - 5 x 10 cm
• 1 x Y oblik - 5 x 25 cm
Šifra
GSPKTPP-006

• 1 x I oblik - 5 x 25 cm
• 1 x ŠAPA oblik - 5 x 10 cm

Oblik traka:
• 1 x X oblik - 5 x 10 cm
• 1 x Y oblik - 5 x 15 cm
• 1 x I oblik - 5 x 20 cm

Oblik traka:

Šifra
GSPKTPP-006
• 1 x X oblik - 5 x 10 cm
• 1 x Y oblik - 5 x 30 cm
• 1 x I oblik - 5 x 15 cm
postavljene kineziološke trake stimuliraju kožne receptore svaki put kada se pokrenete, a taj stimulirajući efekt prenosi se na mišiće, zglobove i ligamente potičući ih da se aktiviraju na optimalan način. Kada se pravilno postave, omogućavaju i potiču protok limfe u limfni sustav što pozitivno utječe na receptore boli - rezultat je smanjenje i prestanak boli te brže prolaženje edema.
SET ISTIH OBLIKA | 4 komada
Oblik traka: Y
Šifra
GSPKTPP-002-pl
GSPKTPP-002-be
GSPKTPP-002-cr
Tehničke karakteristike:
• Dimenzije: 5 x 25 cm
• Boje: Plava, bež i crna
• 97% pamuk i 3% elastin





SET ISTIH OBLIKA | 4 komada
Oblik traka: ŠAPA
Šifra
GSPKTPP-004-pl
GSPKTPP-004-be
GSPKTPP-004-cr
Tehničke karakteristike:
• Oblik traka: ŠAPA
• Dimenzije: 5 x 15 cm
• Boje: Plava, bež i crna
• 97% pamuk i 3% elastin






Oblik traka:
Šifra
GSPKTPP-008
Šifra
GSPKTPP-009
• 4 x I oblik
- 5 x 20 cm


Oblik traka:
• 1 x X oblik
- 5 x 10 cm
• 1 x ŠAPA oblik
- 5 x 15 cm

Šifra
GSPKTPP-010


Oblik traka:
• 1 x X oblik
- 5 x 10 cm
• 1 x Y oblik - 5 x 30 cm



AED (eng. Automated External Defibrillator) je automatski defibrilator (AVD) napajan baterijom s funkcijom automatskog samotestiranja za vanjsku uporabu. Nakon postavljanja defibrilacijskih jastučića (elektroda) na gola prsa pacijenta, AED automatski obavlja elektrokardiogramsku (EKG) analizu i savjetuje operateru da isporuči električni šok ako je potrebno. AED pruža upute kroz cijeli postupak spašavanja kombinacijom glasovnih odzivnih znakova, zvučnih upozorenja i vizualnih pokazatelja. Glasovne upute na hrvatskom jeziku!
Tehničke karakteristike:
• Dizajniran za javnu uporabu u slučaju hitne medicinske situacije
• Jednostavna, brza, učinkovita i praktična uporaba - mogu se njime služiti i laici
• EKG analiza: procjenjuje EKG ritmove, analizira pacijentova prsa kroz otpor elektroda i odlučuje hoće li defibrilacija biti potrebna ili ne
• Trajanje analize: 4 - 15 sekundi
• Kučište od ABS plastike štiti od udaraca, prašine i prskanja vode
• Standardna energija: 200 J
• Može se primjeniti na djeci i odraslima
• Bifazična tehnologija
• Impedancija: 20 - 200 Ω
• Funkcija automatskog samotestiranja
Defibrilator SAVER ONE AED D
Šifra

Defibrilator SAVER ONE PAD
Šifra SVO-B0847
• Ritmovi kod kojih je moguća primjena šoka: ventrikulska fibrilacija (VF) i ventrikulska tahikardija (VT)
• Osvijetljene oznake pomažu rukovatelju u primjeni uređaja
• Snimanje i prijenos podataka pomoću unutarnje memorije, memorijske kartice, USB memorije
• Dugotrajna baterija LiMnO2 omogućuje maksimalnu mobilnost: dovoljna je za 300 potpunih ciklusa reanimacije
• Baterija ima dugi vijek trajanja, no potrebno ju je puniti pripadajućim punjačem (SAV-C0012) i ostalim priborom isporučenim od AIM Italia Srl.
• Dimenzije: 26,5 × 21,5 ×7,5 cm
• Praktična torbica
• Jamstvo: 5 godina

Malen, lagan i izdržljiv defibrilator za profesionalnu uporabu na otvorenom i u teškim uvjetima. Pouzdan. Šifra za osposobljeno osoblje. Način rada “AED”: omogućuje korisniku da na interaktivnom zaslonu u boji (12 × 8 cm) promatra EKG krivulju prilikom defibrilacije. Način rada “ECG Monitoring”: omogućuje prikaz srčanog ritma i pulsa dok rukovatelj upotrebljava elektrode za defibrilaciju ili standardne EKG elektrode spojene s odvojenim kabelom. Upute spašavateljima: grafičko sučelje + glasovne naredbe. Dugotrajna baterija LiMnO2 omogućuje maksimalnu mobilnost: dovoljna je za 250 potpunih ciklusa reanimacije. EKG analiza: procjenjuje EKG ritmove, analizira pacijentova prsa kroz otpor elektroda i odlučuje hoće li defibrilacija biti potrebna. Trajanje analize: 4 - 15 sekundi.
Tehničke karakteristike:
• Kućište od ABS plastike štiti od udaraca, prašine i prskanja vode.
• Standardna energija: 200 J.
• Može se primijeniti na djeci i odraslima.
• Bifazična tehnologija.
• Impedancija: 20 – 200 Ω
• Ritmovi kod kojih je moguća primjena šoka: ventrikulska fibrilacija (VF) i ventrikulska tahikardija (VT)
• Funkcija automatskog samotestiranja jamči funkcionalnost u svakom trenutku: uređaj provjerava sve glavne komponente


Defibrilator SAVER ONE AED P

Profesionalni defibrilator za uporabu u različitim uvjetima. 3 načina rada: automatski vanjski defibrilator, ručni defibrilator, uređaj za praćenje rada srca. Dugotrajna baterija LiMnO2 omogućuje maksimalnu mobilnost: dovoljna je za 250 potpunih ciklusa reanimacije. Upute spašavateljima: grafičko sučelje + glasovne naredbe. EKG analiza: procjenjuje EKG ritmove, analizira pacijentova prsa kroz otpor elektroda i odlučuje hoće li defibrilacija biti potrebna. Trajanje analize: 4 - 15 sekundi. Kućište od ABS plastike štiti od udaraca, prašine i prskanja vode.
Tehničke karakteristike:
• Standardna energija: 200 J, može se primijeniti i na djeci i na odraslima, bifazična tehnologija, impedancija: 20 – 200 Ω.
• Ritmovi kod kojih je moguća primjena šoka: ventrikulska fibrilacija (VF), ventrikulska tahikardija (VT), supraventrikulska tahikardija (PSVT).
• Funkcija automatskog samotestiranja; informacije na zaslonu: stanje baterije, indikator dostupne memorije, aktivacija mikrofona, datum i vrijeme.
• Snimanje i prijenos podataka pomoću unutarnje memorije, memorijske kartice, USB memorije ili IrDA porta..
• Dimenzije: 26,5 ×21,5 × 7,5 cm
• Jamstvo: 5 godina
AMI Smarty Saver potpuno automatski defibrilator na hrvatskom jeziku
Šifra
SM2-B1002
Potpuno automatski model, koji, kada je spreman za aplikaciju šoka, automatski će ga isporučiti nakon 5 sekundi shodno glasovnoj uputi. Glasovne upute na hrvatskom jeziku!
Tehničke karakteristike:
• Garancija uređaj: 5 godina
• Garancija baterija: cca. 3 godine

• Dimenzije: 200 mm x 213 mm x 71 mm (sklopljena ručka) | 257mm x 231 mm x 71 mm (otvorena ručka)
• Težina: 1,56 kg
• Radna temperatura: Od 0°C do 45°C
• Temperatura skladištenja i prijevoza: Od-40°C do 70°C
• Vlažnost: Od 10% do 95% relativna vlažnost bez kondenzacije
• Brtvljenje (IP zaštita): IEC/EN 60529: klasa IP56
• Šok/Pad: Izdržljivost zlouporabe: IEC/EN 60601-1 klauzula 21 Elektrostatička pražnjenja: IEC/EN 61000-4-2
Elektromagnetska kompatibilnost: IEC/EN 60601-1-2:2015
Zaštita od defibrilacije: IEC/EN 60601-1; uređaj s internim napajanjem, tip BF
• Klasifikacija: Direktiva 93/42/CEE; Izmjena 2007/47/CE: Klasa IIb, Aneks IX Pravilo 9

Nepunjiva jednokratna Li-SOCI2 baterija
SAV-C0903 za Saver ONE defibrilatore
Šifra
SAV-C0903

Nepunjiva baterija SAV-C0903 (Li-SOCI2) namijenjena je za upotrebu s defibrilatorima serije Saver One. Li-SOCI2 baterija SAV-C0903 spada u kategoriju nove generacije dugovječnih baterija i kao takva unutar predviđenog roka trajanja eliminira bilo kakvu potrebu za održavanjem.
Okvirne mogućnosti Li-SOCI2 baterije u određenom režimu rada:
• 200 J energije i CPR cca 300 ciklusa spašavanja
• 360 J energije i CPR cca 200 ciklusa spašavanja
• EKG mod praćenja cca 35 sati rada
• Trajnost baterije
5 godina ako se čuva u originalnom pakiranju
4 godine nakon ugradnje u AED (defibrilator)
Jednokratne elektrode za defibrilatore Saver One
Šifra Opis
SAV-C0846 za odrasle
SAV-C0016 za djecu
Elektrode su namijenjene za defibrilatore Ami Italija Saver One. Od 8 godina starosti ili 25 kg težine, 81 cm2 provodljive površine.


AMI Li-MnO2 baterija za Smarty Saver defibrilatore
Šifra
SMT-C14031

Jednokratna Li-MnO2 baterija s 8 ćelija za Smarty Saver defibrilatore, napona i kapaciteta - 12VDC-3000mAh.
Tehničke karakteristike:
• Napon i kapacitet: 12VDC-3000mAh
• Autonomija baterije: Do 200 kompletnih ciklusa spašavanja (200 J šokovi + CPR); Do 36 sati kontinuirane analize EKG-a
• Stand by life baterije (* Učinak se odnosi na nove baterije pohranjene na temperaturi od 20°C i relativnoj vlažnosti od 45% bez kondenzacije): Do 3 godine s testom umetanja baterije i svakodnevnim samotestiranjem bez uključivanja AED-a
Jednokratne elektrode za AMI Smarty Saver defibrilatore
• Dimenzije: Ukupna površina 136 cm2 Aktivna površina 94 cm2
• Rok trajanja: 24 - 30 mjeseci, kako je naznačeno na pakiranju

Šifra
07.1.5766.03
DefiSign LIFE defibrilator osmišljen je kako bi se njime mogli koristiti sve osobe bez predhodnog znanja o defibrilaciji. Defibrilator daje jasne verbalne upute na hrvatskom jeziku kroz svaki korak procesa oživljavanja. AED (defibrilator) počinje raditi čim se otvori prednji poklopac, počevši s jasnim izgovorenim uputama, podržanim slikama koje su istaknute LED svjetlima. AED korak po korak objašnjava što treba učiniti, čineći DefiSign LIFE iznimno lakim za korištenje. Elektrode su jasno vidljive i dostupne, unaprijed su spojene na AED, spremne za izravno pričvršćivanje na pacijentova prsa, čime se štede dragocjene sekunde. Elektrode za ovaj AED imaju vijek trajanja od 3 godine, što je zabilježeno na AED-u; kada elektrodama istekne rok trajanja, AED će vas upozoriti da ih treba zamijeniti. Baterija ima vijek trajanja od 6 godina.
Tehničke karakteristike:
• Tip: Automatski defibrilator
• Garancija uređaj: 10 godina
• Garancija baterija: cca. 6 godina
• Garancija elektrode: cca. 3 godine
• Dimenzije: 31 x 25,5 x 10 mm
• Težina: 2,5 kg
• IP oznaka: 55
• CPR povratne informacije: Audio, metronom



Šifra
AMI VOR
Jednostavna kombinacija za zaštitu i nadgledanje vašeg AED uređaja u realnom vremenu.
AED Guard sistem
Postavljanje zvučnog alarma za otvaranje vrata: Moguće je postaviti vrijeme aktivacije i ritam alarma prema vlastitim željama. Slanje email poruke u slučaju otvaranja vrata ormarića - ALARM: Nakon otvaranja vrata, šalje se e-mail obavijest s lokacijom i vremenom događaja.
Upozorenje za temperaturu (izvan raspona): AED-Guard modul šalje e-mail obavijest ako temperatura u ormariću premaši unaprijed postavljene limite (koji se mogu postaviti putem oblaka).
Gumb za hitni poziv: Pomoću gumba LIVE, omogućeno je aktiviranje poziva koji se automatski povezuje s tri telefonska broja, jedan za drugim.
Geolokacija: omogućuje prikaz lokacije postaje za spašavanje, čime se olakšava identificiranje lokacije žrtve.

AED Guard modul Nadograđuje svaki AED uređaj s geolokacijskim značajkama
Gumb za hitni poziv: Pomoću gumba LIVE, omogućeno je aktiviranje poziva koji se automatski povezuje s tri telefonska broja, jedan za drugim.
Geolokacija: omogućuje prikaz lokacije postaje za spašavanje, čime se olakšava identificiranje lokacije žrtve.

S nano SIM karticom, GSM/4G, WiFi i GNSS povezivanjem, uređaj je kompatibilan s AMI SAVER CLOUD platformom. Provjera statusa AED-a (24h): neprekidno prati status AED uređaja i šalje e-mail obavijest u slučaju kvara.
Šifra
Ormarić je opremljen s dva para LED žaruljica koja su uvijek uključena. Kada se ormarić otvori, svjetla počinju treperiti dok se alarm ne deaktivira Sustav grijanja održava radnu temperaturu defibrilatora unutar određenih granica. Grijač će automatski zagrijavati ormarić kada unutarnja temperatura padne ispod 6°C, te će se automatski isključiti kada temperatura dosegne približno 9°C. Ventilacijski sustav omogućava odvođenje toplog zraka iz ormarića i automatski će se aktivirati kada unutarnji termometar očita temperaturu od 40°C. Ventilacija će se deaktivirati kada temperatura padne na približno 37°C.




Mehaničke karakteristike:
• Ukupna težina (bez AED-a): 10 kg
• Materijali:
- Kućište i vrata: pocinčani čelik, debljine 1,5 mm, premazan prahom
- Otvor na vratima: PMMA (polimetil-metakrilat), debljine 5 mm
• Tehničke značajke
- Napajanje: 24 V Meanwell IP 67, 60 W, 2,5 A (uključeno)
- Potrošnja energije: 2,5 A
- Snaga zvuka alarma: 105 dB na udaljenosti od 1 metra
• Radni uvjeti – temperatura i vlažnost:
- Minimalna temperatura: -20°C
- Maksimalna temperatura: 55°C
- Pokretanje grijanja: pri temperaturi manjoj ili jednakoj 6°C
- Automatsko pokretanje ventilacije: pri temperaturi većoj ili jednakoj 40°C
Ormarić za AED defibrilator napravljen je od plastificiranog čeličnog lima. Dimenzije ormarića: 37x37x17cm.
Napravljen je od polistirena koji je visoko otporan na vanjske utjecaje. Štiti AED od svih vrsta vremenskih uvjeta. 100% otporan na prašinu i vodonepropusan. Zidni ormarić s ključem za defibrilator

ormarić za defibrilator s alarmom - AED vanjski

07.1.3580.00
07.1.3661.00 XD AED
07.1.5653.00 XD SPO2
07.1.5654.00 XD PACER
07.1.5655.00 XD PACER, SPO2
07.1.5656.00 XD AED, PACER
07.1.1264.00 XD AED, SPO2
07.1.5657.00 XD AED, PACER, SPO2

Primedic defibrilator – DefiMonitor XD, za profesionalnu upotrebu. DefiMonitor XD kombinira dizajn uređaja koji je kompaktan, dokazan i pouzdan u praksi s najvećim mogućim stupnjem sigurnosti i jednostavnim rukovanjem, čak i u ekstremnim situacijama. Intuitivan i jednostavan za korištenje s LCD mo-

Prijenosni poluautomatski vanjski defibrilator. CCD (strujno regulirana) bifazična tehnologija valnog oblika. Energija od 140 – 360 J. Vrijeme punjenja: < 12 sekundi. Pre-gelirane samoljepljive elektrode za defibrilaciju. Jasno glasovno i vizualno navođenje. ECG odvod – Eindhoven II. Prepoznavanje VF / VT. Vrijeme analize 7-12 sekundi. VF prag osjetljivost 200 µV. Prag asystole < 200 µV. Detekcija artefakta. Detekcija pacemaker-a. Dimenzije : 250x2800x90 mm / težina 2 kg.

Prijenosni poluautomatski vanjski defibrilator CCD (strujno regulirana) bifazična tehnologija valnog oblika. Energija od 140 – 360 J. Pre-gelirane samoljepljive elektrode za defibrilaciju. Jasno glasovno i vizualno navođenje na hrvatskom jeziku. Vrijeme punjenja < 20 sekundi. Prepoznavanje VF u vremenu < 7 sekundi. VF prag osjetljivost 200 µV. Prag asystole < 200 µV. Detekcija artefakta. Detekcija pacemaker-a Zapis 100 sati podataka / glasa na izmjenljivu CF karticu. Automatski self-test, periodički self-test, test iniciran od operatera. Napajanje LiMnO2 baterije 15V, 2 Ah / trajnost 3 godine, omogućuje 100 šokova / 360J, punjač 220V/50Hz. Dimenzije : 250x280x90 mm / težina 2 kg.

nitorom visoke razlučivosti od 5,7 inča. Glasovne upute i precizni metronom prikazuju se tijekom cijelog procesa defibrilacije. Nakon što je analiza dovršena i uređaj je odobren za upotrebu, defibrilacija se pokreće pritiskom na tipku za šok. SpO2-mjerenje Nellcor tehnologijom. Težina: 5,3 kg (bez baterije).

Uređaj za edukaciju defibrilacije. Primedic HeartSave PAD ima odlične specifikacije te dolazi s prigodnom tipkom za lakši prijelaz na način rada prilagođen za dječje pacijente. Uređaj je veoma izdržljiv, njemačke izrade, te je njime veoma lako upravljati. Sve funkcije uređaja su jasno naznačene na njegovom prednjem dijelu. Uključeno uz uređaj: Baterija radnog vijeka 3 godine. Elektrode. Podatkovna kartica i program za pohranjivanje i čitanje EKG podataka. AED protokolna lista. Komplet za hitnu pomoć: škare za rezanje odjeće, britvica, sterilne maramice, zaštitne maramice, maska za reanimaciju.

Za primjenu na odraslima i na djeci. Uporaba samo jedne vrste jednokratnih elektroda - funkcija prepoznavanja elektroda za djecu ili za odrasle. Jednostavna uporaba u tri koraka. Glasovne upute na hrvatskom jeziku, s mogućnošću promjene na engleski, njemački, španjolski, francuski i dr. europske jezike. Funkcija brze defibrilacije i dvofazne defibrilacije. Dvofazna tehnologija smanjuje vjerojatnost oštećenja srčanog mišića. U komplet su uključeni: Baterija za AED-3100, vijek trajanja 4 godine (SB-310V). Jednokratne PAD elektrode, odrasli/djeca (P-740K).

TABLICA
DEFIBRILACIJA
Impuls dvofazni tok
Energija (automatski način rada) 140 - 360 J
Energija (ručni način rada) 5 - 360 J
Vrijeme punjenja između udara <6 s / 200 J
Način rada sinkroni/asinkroni
EKG: 6-KANALNI
KANALI: Eindhoven I,
Goldberger aVL, aVR, aVF
Raspon impendancije pacijenta 23 - 200
Alarm 30 - 300 u minuti
Broj otkucaja srca 30 - 300 u minuti
DETEKCIJA VF/VT
Detekcija VF
Trajanje analize 7 - 12 sekundi
Prag za VF 0,2 mV
Prag za asistoliju < 0,2 mV
Detekcija vanjskih smetnji
Detekcija elektrostimulatora srca
PULSNI OKSIMETAR NellCor OxiMax
LCD ZASLON plavo osvjetljenje
115 × 86 mm dijagonala 4,7'’
Rezolucija 320 × 240 px
ELEKTROSTIMULATOR SRCA vanjski
QRS-marker
Način rada: fiksni, na zahtjev ručno zaustavljanje
Elektrode za defibrilator
Samoljepljive elektrode vijek trajanja 3 g.
Dužina kabela 1,5 m
Ugrađene elektrode za djecu
SNIMANJE KOPIJA PODATAKA
Uklonjiva mem. kartica (2 GB)
Aktivno/neaktivno audio snimanje
Software za pregled EKGsnimaka
Pisač: izravni termalni ispis
Širina papira: 58 mm
Širina ispisa: 50 mm
Brzina ispisa: 25 - 50 mm/s
NAPAJANJE: AKUPAK
NiCd 12 V, 1,4 Ah vijek trajanja 3 g.
Pražnjenje: 60 na 360 J
Praćenje: 5 h
Vrijeme punjenja: 3 h za vanjske, 1 h za unutarnje baterije
Dimenzije: 26 × 26 × 9 cm
Težina: cca 4,5 kg
TABLICA SPECIFIKACIJA DEFIBRILATORA PRIMEDIC HEARTSAVE
DEFIBRILACIJA
Val dvofazni, kontrola pulsa
Energija 140 - 360 J
Vrijeme punjenja između udara < 6 sekundi
Vrijeme punjenja između udara < 12 sekundi
Način rada sinkroni/asinkroni
automatski
EKG
Kanali Eindhoven II
I, II, II, aVR, aVF, aVL
Raspon impendancije pacijenta 20 - 200
Broj otkucaja srca 30 - 300 u min
DETEKCIJA VF/VT
Prekidač za ručno zaustavljanje
Trajanje analize 6 - 12 sekundi
Prag za VF 0,2 mV
Prag za asistoliju <0,2 mV
Detekcija vanjskih smetnji / elektrostimulatora srca
PULSNI OKSIMETAR NellCor OxiMax
LCD ZASLON
92 × 72 mm (dijagonala 4,7'')
Rezolucija: 320 × 240
Prikaz stanja baterije
Broj otkucaja srca, broj defibrilacija, broj detekcija VF/VT, vrijeme reanimacije
ELEKTRODE
Nepolarizirane elektrode, vijek trajanja 3 godine
Duljina kabela: 1,5 m
SNIMANJE KOPIJA PODATAKA
Uklonjiva memorijska kartica
Snimanje zvuka i podataka: 100h
Aktivno/neaktivno audio snimanje
NAPAJANJE
LiMnO2, 15 V, 2 Ah, trajanje 3 g.
Pražnjenje: 100 na 360 J
LiMnO2, 15 V, 2,8 Ah, traj. 6 g.
Pražnjenje: 200 na 360 J
Dimenzije: 25 × 28 × 9 cm

Šifra
Značajke modela MCC-E:
• Učinkovitost – Povećava učinkovitost reanimacije
• Inteligencija – Pametni alat za reanimaciju
• Sigurnost – Nizak rizik od prekomjerne kompresije
• Praktičnost – Prilagođen za složene uvjete
Povećava učinkovitost reanimacije
• 3D tehnologija kompresije, patentirana od strane Weil instituta za istraživanje i inovaciju u kritičnoj skrbi, spaja prednosti srčanog i torakalnog pumpnog mehanizma, stvarajući treću generaciju reanimacijske tehnologije. SunLife i Weil institut surađuju na kliničkoj primjeni ove tehnologije.
Elektronička upravljačka jedinica
• Omogućuje vidljivu i potpuno kontroliranu reanimaciju zahvaljujući 2,8-inčnom OLED zaslonu koji u stvarnom vremenu prikazuje podatke o kompresiji.
• Prilagodljiva dubina i brzina kompresije omogućuju personalizirani tretman i znanstveno istraživanje.
• Statistika CCF-a i ostalih podataka o reanimaciji može se generirati odmah nakon završetka postupka.
• Velika memorija s kapacitetom za pohranu do 180 sati podataka.
• Podržava višekanalni prijenos podataka putem USB-a, WiFi-a i Bluetootha.
• CPR podatkovni oblak omogućuje pristup registru događaja srčanog zastoja na regionalnoj razini.
Parametri prikaza upravljačke jedinice:
• Brzina i dubina kompresije, način rada, vrijeme reanimacije, broj događaja, status baterije, status bežične veze.
Prilagodljivi parametri:


• Brzina kompresije, dubina, način rada, datum i vrijeme, način prijenosa podataka, jezik.
Statistički podaci:
• CCF, brzina i dubina kompresije, vrijeme reanimacije, vrijeme prekida. Smanjen rizik od ozljeda pri kompresiji
• Soft-start omogućuje postupno povećanje pritiska, smanjujući rizik od prijeloma.
• 3D kompresija kombinira teoriju srčanog i torakalnog pumpnog mehanizma, smanjujući opterećenje kompresije.
• Nisko težište (<15 cm) sprječava prevrtanje i ozljede pacijenta tijekom brzog kretanja.
• Baterija omogućuje 60 minuta rada, a uređaj može raditi i tijekom punjenja, omogućujući neprekinutu kompresiju.
Prilagođen za složene uvjete
• IP34 i EN1789 certifikat.
• Omogućuje rad pod kutem nagiba od 45° za CPR s podignutom glavom.
• Primjenjiv za pripremu ECPR, liječenje hipotermije i PCI tretmane.
• Razdvajanje funkcija kompresije i upravljanja putem pametne upravljačke ploče.
Primjena:
• Prije dolaska u bolnicu
• U bolničkim uvjetima


Tip kompresije
Treća generacija; 3D kompresijska tehnologija
Treća generacija; 3D kompresijska tehnologija
Težina (s baterijom) 3,2 kg 3,2 kg
Brzina kompresije 102 ± 1 kompresija u minuti
Dubina kompresije 52 ± 2 mm
Izvor napajanja
Životni vijek baterije
Baterija: 60 min; AC: 110~240 V, 50~60Hz
300 ciklusa punjenja/pražnjenja
100 do 120 ± 1 kompresija u minuti (podesiva u koracima od 1 kompresije po minuti)
Tvorničke postavke: 102 ± 1 kompresija u minuti
30~55 mm (podesiva u koracima od 1 mm)
Tvorničke postavke: 52 ± 2 mm
Baterija: 60 min; AC: 110~240 V, 50~60Hz
300 ciklusa punjenja/pražnjenja
Zaslon Ne Da
Prikaz na zaslonu /
1) Način kompresije; 2) Brzina kompresije; 3) Dubina kompresije; 4) Broj događaja; 5) Ukupno vrijeme reanimacije; 6) Vrijeme pauze; 7) CCF (frakcija kompresije prsa); 8) Status baterije; 9) Bluetooth/WiFi status
Laringoskop
Šifra Opis
34301-GIM set 2 Miller lopatice veličine 0-1 | pedijatrijski
34302-GIM set 3 Macintosh lopatice veličine 2-3-4 | za odrasle
Opremljen standardnom vakuumskom žaruljom od 2,5 V. Lagana i ergonomski oblikovana drška satenske završne obrade. Spojevi od nehrđajućeg čelika jamče dug vijek trajanja. Set je pakiran u kutiju otpornu na udarce. Drška od 2,5 V radi s alkalnim ili punjivim baterijama. Vrlo dobar prijenos svjetlosti od 3.500 LUX uz pomoć 2,5 V drške. Lopatice laringoskopa proizvedene su od antimagnetskog nehrđajućeg čelika 18/8 kvalitete tipa AISI 303/304 koji je vrlo otporan na koroziju i u skladu je sa ISO standardom 7376 koji omogućuje korištenje s drškama drugih marki. Jednostavna ETO sterilizacija (sterilizacija etilen oksidom) ili sterilizacija parom . Mogu se sterilizirati u autoklavu na 134 °C u trajanju od 5 minuta (moguće do 2.000 ciklusa u autoklavu).




Heine XP laringoskop set za hitnu pomoć
Šifra
Kompletan set laringoskopa HEINE XP dizajniran za hitnu uporabu. HEINE XP s 5 različitih lopatica za novorođenčad i odrasle. Spreman za korištenje s baterijskom drškom s optičkim vlaknima. HEINE XP laringoskopski set sadrži XP lopatice s ugrađenim optičkim vlaknima. Paket uključuje torbicu za nošenje, 5 jednokratnih lopatica (za sprječavanje kontaminacije) Miller 0, Miller 1, Mac 2, Mac 3, Mac 4, F.O. SP 2,5V ručku i 2 alkalne baterije. Izuzetno jako osvjetljenje s XHL halogenom svjetiljkom. Svjetlost je precizno usmjerena na epiglotis i glasnice.






Drška za metalnu lopaticu laringoskopa Kawe (F.O.)
Šifra Opis
07.2.3130.00 FO, Ø 19 mm
07.2.3131.00 FO, Ø 28 mm
07.2.5386.00 Standard, Ø 28 mm
7.2.5387.00 High Power, Ø 28 mm


Plastična drška laringoskopa
Šifra
07.2.5746.00
Jednokratne plastične lopatice (F.O.)
Šifra Opis
07.2.5747.00 0 - Miller
07.2.5748.00 1 - Miller
07.2.5749.00 2- Macintosh
07.2.5750.00 3- Macintosh
07.2.5751.00 4- Macintosh


Metalne lopatice za laringoskop KaWe, standardna (C)
Šifra Vel.
07.2.3124.01 0
07.2.3124.02 1
07.2.3124.03 2
07.2.3124.04 3
07.2.3124.05 4
07.2.3124.06 5

Metalne lopatice za laringoskop KaWe, (F.O.)
Šifra Vel.
07.2.3135.01 0
07.2.3135.02

07.2.3135.05 4
Metalna lopatica za laringoskop KaWe, (F.O.), TEPRO* vel. 4

Metalne lopatice za laringoskop KaWe FLAPLIGHT®, Macintosh, standardna (C)
Šifra Vel.
07.2.1473.01 3
07.2.1473.02 4
Fleksibilna lopatica - savijanje do 60°. Lakše podizanje epiglotisa i uvođenje instrumenta i kod teških povreda. Bolja preglednost i smanjeni efekt poluge. Jednostavna zamjena žaruljica.

Metalna lopatica za laringoskop KaWe FLAPLIGHT®, Macintosh, opt. vlakna (F.O.)
Šifra Vel.
07.2.2264.01 1
07.2.2264.02 2
Fleksibilna lopatica - savijanje do 60°. Lakše podizanje epiglotisa i uvođenje instrumenta i kod teških povreda. Bolja preglednost i smanjeni efekt poluge. Jednostavna zamjena žaruljica. 07.2.3124.07 | vel.00
Koferi Kawe za laringoskope
Šifra Opis
07.2.0143.00 Tri lopatice i jedna drška
07.2.0144.00 Pet lopatica i jedna drška
Torba za četiri lopatice i jednu dršku
Šifra
07.2.0441.00



Baterija za laringoskop KaWe, Ø 28 mm
Šifra
07.2.1228.00

Žaruljice za laringoskop KaWe
Šifra Opis
07.2.0527.00 za dršku vel. 00, 0, 1 07.2.0528.00 za dršku vel. 2, 3, 4, 5
07.2.5740.00 za F.O. modele, 2,5 V 07.2.4464.00 za F.O. modele, 3,5 V


AMBU Set za reanimaciju
Šifra Opis
07.2.2373.00 Adapter za PEEP-ventil
07.2.0636.00 Samošireći balon AMBU
07.2.1775.00 PEEP-VENTIL ZA AMBU samošireći balon
07.1.3030.00 Maska za reanimaciju AMBU | vel.0
07.2.5442.01
07.2.5442.02
07.2.5442.03
Maska za reanimaciju AMBU | vel.2
Maska za reanimaciju AMBU | vel.3/4
Maska za reanimaciju AMBU | vel.5
Sastoji se od PEEP ventila, adaptera za PEEP ventil, AMBU IV širećeg balona, filtera te maske za reanimaciju i adaptera za istu.
Adapter za PEEP-ventil:
• Za silikonske samošireće balone
• Podesiv od 1,5 do 20 H2O cm
• Konektor od 30 mm
Samošireći balon AMBU:

• Maska s jednosmjernim ventilom samošireći balon za odrasle i djecu težu od 15 kg
• Dvije komorice s ograničenjem pritiska do 70 mbara
• Dvoslojna izrada. 100% bez lateksa
• Moguća sterilizacija u autoklavu
PEEP-VENTIL ZA AMBU samošireći balon:
• 2 - 10 H2O cm
• Narančasta boja
• Konektor od 30 mm




Silikonski reanimator sa priborom
Šifra Opis
70-555-01 za odrasle
70-555-02 za djecu
70-555-03 za dojenčad
Silikonski reanimator
Šifra Opis
70-555-04 za odrasle
70-555-05 za djecu
70-555-06 za dojenčad
Set za reanimaciju
Šifra Opis
RA141 za odrasle
RA142 za djecu
Mogućnost steriliziranja u autoklavu. Komplet sadrži: 1 silikonski balon s ventilom za reanimaciju (može se sterilizirati u autoklavu), 1 cijev za dovod kisika, 1 silikonska maska za lice ( vel. 5 / vel. 3 / vel. 1), 1 spremnik ( 2700 ml/ 2700 ml / 900 ml), 2 Guedel kanile (vel. 3/4, vel. 1/2, vel. 000/00), 1 torba za transport.

Samošireći balon za reanimaciju bez maske, PVC
Šifra RA411


Za jednokratnu upotrebu, za odrasle. Kapacitet 1800 ml, ventil 60 ml H2O.

Samošireći balon za reanimaciju, silikonski
Šifra Opis
RA401 za odrasle
RA403 za djecu
Mogućnost steriliziranja u autoklavu na 121°C.



Samošireći balon za reanimaciju, gumeni, 2 komore
Šifra
07.2.0722.00

PVC vrećica za kisik za samošireći balon za reanimaciju
Šifra Opis
RA523 za dojenčad
RA520 za odrasle


Samošireći balon za reanimaciju, silikonski
Šifra Opis
07.2.1362.01 za dojenčad
07.2.1362.02 za odrasle
07.2.1362.03 za djecu
Može se sterilizirati u autoklavu. S ventilom koji regulira tlak. Brzo rastavljanje i čišćenje.

Maska za anesteziju
Šifra Veličina
70-555-46 1
70-555-47 2
70-555-48 3
70-555-49 4
70-555-50 5
70-555-51 6

Maska za reanimaciju, gumena, za odrasle
Šifra
07.2.1359.00
Mogućnost steriliziranja u autoklavu.


Samošireći balon za reanimaciju, PVC
Šifra Opis
07.2.1362.01 za dojenčad
07.2.2909.02 za odrasle
07.2.2909.03 za djecu
Za jednokratnu upotrebu.



Maska za oživljavanje s nepovratnim ventilom u PVC kutiji

Plastični otvarač za usta

Folija za umjetno disanje na privjesku

Šifra Opis
07.2.5742.00 za djecu
07.2.2905.00 za odrasle

Konikotomija je tehnika otvaranja dišnog puta. Vrši se punkcijom ili incizijom krikotireoidne membrane i uvođenjem cjevčice koja će napravljeni otvor održati otvorenim, odnosno stvoriti novi dišni put, u slučajevima kada traheotomija nije moguća. Set za punkcijsku konikotomiju. Kanila je anatomski oblikovana, može se direktno spojiti sa samoširećim balonom nakon vađenja metalne igle-vodilice (troakar) i ima krilca za fiksaciju okovratnom trakom. Širina igle je 2 mm za djecu, a 4 mm za odrasle. Namijenjeni su za jednokratnu upotrebu.
Komplet za konikotomiju
Šifra
07.2.2306.00
TUBUS PO MAYOU-nesterilni
Šifra Opis
57752-GIM veličina 00 | 50 kom | plava
57753-GIM veličina 0 | 50 kom | crna
57754-GIM veličina 1 | 50 kom | bijela
57755-GIM veličina 2 | 50 kom | zelena
57756-GIM veličina 3 | 50 kom | žuta
57757-GIM veličina 4 | 50 kom | crvena
57758-GIM veličina 5 | 50 kom | narančasta


TUBUS PO MAYOU-nesterilni
Šifra Opis
10.0.5843.01 18 CH
10.0.5843.03 28 CH
10.0.5843.04 30 CH
10.0.5843.05 24 CH

Šifra Opis
07.2.2510.01 vel. 3 (<155 cm)
07.2.2510.02 vel. 4 (155 - 180 cm)
07.2.2510.03 vel. 5 (>180 cm)
07.2.2510.04 vel. 2 (12-25 kg)
07.2.2510.05 vel. 2,5 (125-150 cm)
07.2.2510.06 vel. 1 (5-12 kg)
07.2.2510.07 vel. 0 (<5 kg)
Šifra Opis
07.2.3666.01 veličina 1
07.2.3666.02 veličina 2
07.2.3666.03 veličina 5
Šifra Opis
07.2.3560.01 veličina 3
07.2.3560.02 veličina 4
07.2.3560.03 veličina 5




Ormarić za prvu pomoć, PLASTIČNI
Šifra Opis
P14-0037 Pun
P14-0037B Prazan
Plastični ormarić za prvu pomoć izrađen je od PVC-a. Moguće ga je postaviti na zid. Ormarić ima police na kojima je složeno 14 različitih artikala, u raznim količinima prema europskim direktivama. Ormarić sadrži sve elemente prve pomoći potrebne u hitnom slučaju.

Punjenje ormarića prve pomoći
Šifra
P10-0061
Punjenje za ormarić prve pomoći sadrži 16 različitih artikala. Ovo punjenje možete koristiti u praznom metalnom ormariću za prvu pomoć, praznom plastičnom ormariću za prvu pomoć ili u torbici za prvu pomoć.
Šifra
GM00200D

Ormarić za prvu pomoć,
Šifra Opis
P14M-00140 Pun P14M-00140B Prazan
Metalni ormarić za prvu pomoć s prednje strane ima bravicu s ključem. Moguće ga je postaviti na zid. Ormarić ima police na kojima je složeno 17 artikala, u propisanim količinama. Oramarić sadrži sve elemente prve pomoći koji su u hitnom slučaju potrebni. Dimenzije: 370 x 300 x 150mm

P7-0007
Plastični auto-ormarić za prvu pomoć sadrži 12 različitih artikala od kojih su neki sadržani više puta. Ormarić za prvu pomoć sadrži najvažnije elemente prve pomoći koji su u hitnom slučaju potrebni.

Komplet za porođaj (Dok Kit) je neophodan pribor za sve hitne službe i medicinske torbe, ali i za korištenje u vozilima javnog prijevoza, avionima, brodovima i vlakovima. Zauzima malo prostora, ima dug vijek trajanja i sadrži sve što je potrebno za adekvatnu pomoć pri porođaju.
Komplet sadrži:
• Dimenzije: 330x85x400 ± 10mm
• Težina: 600 ± 20g
• Certifikati: MD CE oznaka po dir. 93/42/CE
• Sadržaj DOK KIT-a: Papirnati ručnici 40×40 cm, sklopljeni 8 komada
• Sterilne plastične stezaljke za pupčanu vrpcu: 2 komada
• Gumena šprica: 1 komad
• Škare za pupčanu vrpcu: 1 komad
• Vodootporna pelena: 1 komad
• Upijajuća podloga 60×90 cm: 1 komad
• Sterilne gazne komprese 10×10 cm: 6 komada
• Jednokratne sterilne latex rukavice: 1 par
• GMX 401 – dezinficijenski ručnik: 8 komada Torbe

Izrađen od čvrstog najlonskog materijala. Prostrana unutrašnjost s remenčićima za pričvršćivanje i odjeljcima za manje instrumente. Dimenzije: 44 × 36 × 17 cm.

Materijal otporan na trganje s patentnim zatvaračem, sigurnosna protuklizna površina. Dodatni bočni i prednji pretinci.

• Materijal: poliester, PVC
• Boja: crvena
• Veličina: 65 x 35 x 35 cm
• Unutarnji modularni prostori: 6
• Vanjski džepovi: 5

• Materijal: poliester, PVC
• Boja: crvena
• Veličina: 45x28x 28 cm
• Unutarnji modularni prostori: 3
• Vanjski džepovi: 4

Ruksak za hitnu pomoć | prazan
• Materijal: poliester, PVC
• Boja: plava
• Veličina: 55 x 35 x 32 cm
• Unutarnji modularni prostori: 6
• Vanjski džepovi: 4

• Materijal: poliester, PVC
• Boja: crvena
• Veličina: 55 x 35 x 32 cm
• Unutarnji modularni prostori: 6
• Vanjski džepovi: 4
Gornji dio s pretincima i trakama za učvrščivanje. Materijal otporan na trganje s patentnim zatvaračem, reflektirajuće trake i sigurnosna protuklizna površina.


Torba za reanimaciju “Compact”


za reanimaciju | prazan
07.3.2351.00
Izrađen od čvrstog, vodootpornog materijala. Prostrana unutrašnjost. Kofer za hitnu pomoć “B”

Komplet sadrži:
• jednokratni balon za reanimaciju
• dvije maske
• otvarač za usta
• tri tubusa po Guedelu
• usisni kateter
• dva kompleta za infuziju
• igle
• štrcaljke

• aspirator s nožnim prekidačem
• tlakomjer
• stetoskop
• laringoskop u kovčežiću
• hemostatsku hvatalicu
• hvatalicu po Magillu
• trahealne tubuse u tri veličine
Komplet sadrži:
• tlakomjer
• stetoskop
• dijagnostičku svjetiljku
• štrcaljke od 5 i 10 ml (10-10 komada)
• igle (100 komada)
• intravenske kanile
• PE rukavice (100 komada)
• špatule (100 komada)
07.3.0977.00
Komplet sadrži:
• jednokratni balon za reanimaciju
• 2 maske
• hvatalicu za jezik
• otvarač za usta
• 3 tubusa po Guedelu
• 3 usisna katetera
• 2 kompleta za infuziju
• povesku za vađenje krvi
• kirurške škarice
• škarice za zavoje
• hemostatsku hvatalicu
• običnu hvatalicu
• kukastu hvatalicu
• antiseptik za kožu
• toplomjer
• komplet za rektalnu primjenu
• vatu, gaze
• katetere

• štrcaljke od 5 i 10 ml
• igle
• dijagnostičku svjetiljku
• 2 para rukavica
• dva kompleta za infuziju
• cjevčicu za hranjenje
• cjevčicu za želudac
• kiruršku masku
• cijev po Mayou
• bubrežastu zdjelicu
• traku za mjerenje
• antiseptički sapun

Nosila za imobilizaciju kralježnice
Šifra D-11
Izrađena od polikarbonatnog materijala. Propusna za X-zra ke. Dimenzije: 183 X 46 X 0,5 cm

Šifra
07.4.2915.00
100% propusna za rendgenske zrake. Mogu se patibilna sa svim vrstama imobilizatora glave, se brzo otkopčavaju. Dimenzije: 183 × 40 × 4,5 cm, težina: 7,6 kg.
Šifra


Polietilen visoke gustoće (PE-HD). Vodootporna, plutajuća nosila. Propusna za X-zrake. Dimenzije: 184 x 44,5 x 6,5 cm; težina: 7,8 kg. Kapacitet: 150 kg.
Prijenosni sling
Šifra
07.4.1200.00

Šest ručki - sigurniji transport pacijenta. PVC obloga. Vodootporan, lako se pere. Propušta rendgenske zrake. Dimenzije: 190 × 60 cm.
Standardna nosila
07.4.1831.00

Vakuumske udlage za imobilizaciju s pumpom
Šifra
07.4.1810.00
Izrađene od čvrstog materijala, ove udlage omogućuju idealnu imobilizaciju donjih i gornjih ekstremiteta pomoću vakuuma. Opremljene usisnim ventilima koji se nalaze s vanjske strane kako bi se izbjegle moguće poteškoće s pacijentom.Komplet uključuje vakuumsku udlagu za ruku, nogu i podlakticu, malu vakuumsku pumpu i najlonsku torbu.

Sklopiva nosila

Sklopiva nosila od aluminijske legure s presvlakom od PVC-a. Sklopiva po dužini i širini. Dimenzije (otvorene): 221x53x15 cm. Dimenzije (zatvorene): 110x15x7 cm.
Sklopiva aluminijska nosila

Anodizirani aluminij. Nosila se mogu sklopiti po dužini. Dolaze s 3 imobilizacijska remena. Kapacitet: 160 kg. Težina: 8 kg. Dimenzije: 167 / 214 x 42 x 7 cm.
Sklopiva nosila


Sklopiva nosila od anodiziranog aluminija s tekstilnom presvlakom. Periva. Sklopiva po dužini i širini. Opremljena sa sigurnosnim remenjem i 4 nožice. Dimenzije (otvorene): 221x53x15 cm. Dimenzije (zatvorene): 110x18x11 cm. Težina: 5 kg. Kapacitet: 160 kg.
Nosila - korito

Izrađena od polietilena s mogućnošću podjele na dvije polovice. Opremljena su: podesivim naslonom za noge, 4 sigurnosna remena, neupijajućim madracem. Sustav blokade za vrijeme prijevoza helikopterom. Dimenzije: 219x62,5x18 cm. Težina: 16,2 kg. Kapacitet: 272 kg.
Vakuum madrac za odrasle

Materijal TPU (termoplastični poliuretan). 4 pojasa i 8 ručki za nošenje. Propusno za X-zrake. Dimenzije 212x75x7 cm. Težina 5 kg. Kapacitet: 160 kg. Uključena pumpa i torba za nošenje.
Sklopiva nosila za hitnu pomoć
Šifra
07.4.2790.00
Okvir od anodiranog aluminija s antikorozivnom zaštitom. Podloga od poliestera presvučena PVC-om, vatrootporna, zaštita od truljenja. Aluminijske nožice. Nosivost: 120 kg; težina: 7 kg. Dimenzije (rastvoreni): 203×50×15 cm. Dimenzije (otvoreni): 96×17×15 cm

Remen za nosila, zatvaranje na čičak
Remen od poliestera za nosila za imobilizaciju, zatvaranje na čičak 5 cm širina.

Imobilizator kralježnice
Šifra
Tekstilna nosila od najlona

10 ručki s ojačanjima. Materijal: najlon. Periva i vodootporna Uključena torba za nošenje dimenzija 60x23 cm. Dimenzije: 200x75 cm, težina 3 kg. Kapacitet: 100 kg.
Krammerova udlaga
Šifra Opis
07.4.0324.00 za nogu
07.4.2058.00 za ruku

Imobilizator kralježnice za odrasle

Idealan za imobilizaciju i izvlačenje unesrećene osobe. Omogućuje horizontalno i vertikalno fiksiranje glave i kralježnice kako bi se smanjila opasnost od ozljeda. Opremljen kopčama i remenjem različitih boja koji olakšavaju korištenje, obloženi jastuk i dvije trake s čičkom za čelo i bradu. Dolazi s torbom za transport.
OXYstabil udlage za imobilizaciju ekstremiteta
Šifra
07.4.3994.00
Koristi se kod ozljeda nogu, gležnja, noge, koljena, lakta, podlaktice i ruke. Za djecu i odrasle. Komplet sadrži: fiksator za odrasle, fiksator za dijete, jedinica za stezanje i jedinica za rastezanje, vijak s 5 razina zatezanja, 3x50 cm traka na čičak, 3 x 35 cm traka na čičak, trokutasta marama, kofer za čuvanje.

Propusno za X-zrake. Opremljen remenjem, materijal: vinilom presvučen najlon s jastukom za glavu. Podesivo stezanje na čičak. Uključena torba za nošenje. Dimenzije: 82x80. Težina 2,5

Univerzalni imobilizator glave
Komplet PVC zračnih udlaga za imobilizaciju
07.4.3253.00 Šifra
Komplet od 6 komada udlaga, torbe za nošenje i male zračne pumpe. Propusno za X-zrake.


Univerzalni imobilizator glave, obložen PVC pjenom. Sastoji se od dva bloka s otvorima za uši, 2 prednja remena i remen za bradu. Dimenzija: 42x26x18 cm; 0,7 kg.

Imobilizator glave FER001

Univerzalni imobilizator glave, može se koristiti s bilo kojim nosilima za imobilizaciju kralježnice ili rasklopnim nosilima. Jednostavno održavanje i prilagođavanje veličini glave pomoću čička.
Okovratnik
Šifra Opis
EM420 Roza - dojenčad (48 x 9,5 cm)
EM421 Svijetlo plava - djeca (48 x 10 cm)
EM422 Ljubičasta - pretili (71,5 x 15 cm)
EM423 Plava - standard (56 x 12 cm)
EM424 Narančasta - medium (62 x 14,5 cm)
EM425 Zelena - visoki (67 x 16,5 cm)
Jednodijelni okovratnik s podesivim stezanjem na čičak. Različite dimenzije i boje ovisno o uzrastu i fizionomiji tijela. Propusno za X-zrake.

Mekani okovratnik 8 cm visina

Mekani okovratnik osigurava blagu potporu vratnoj kralježnci u cilju rasterećenja i smanjivanja boli.
Mekani okovratnik, podesiv, na čičak
Šifra Vel.
40-135-06-medium M
Podloga za umjetno disanje
Podloga je izrađena od polietilena s potporom za glavu. Dimenzije: 64x43x8 cm. Težina: 1,8 kg.

Izotermalni pokrivač za hitnu pomoć
Pokrivač od poliestera sa zlatnom i srebrnom stranom. Srebrna strana štiti od hladnoće, a zlatna od vrućine. Dimenzije: 140 × 220 cm.

Škarice za hitnu pomoć


Višenamjenske škarice koje mogu poslužiti za razbijanje stakla, za rezanje odjeće i sigurnosnih pojaseva. Škarice su od nehrđajućeg čelika i moguće ih je sterilizirati u autoklavu. Dolaze sa zaštitnim koricama.
Trokutasta marama

100 x 100 x 140 cm

Pojasi za fiksaciju
Ovratnik AMBU Perfit

Ima 12 položaja za precizno prilagođeno podešavanje koje pokriva 3 veličine - novorođenčad, djeca i odrasli s uskim vratom. Okovratnik je kompatibilan s radiološkim sustavima kao što su rendgenske snimke, magnetska rezonanca (MR) i kompjutorska tomografija (CT). Stražnji ventilirani dio pogodan je za odvod tekućine.
Okovratnik AMBU Perfit za odrasle
40-135-07-large L Šifra 34641-GIM
Sadrži sustav za jednostavno i točno određivanje veličine - ima 4 standardna položaja i 16 položaja za precizno prilagođeno dodatno podešavanje. Okovratnik je kompatibilan s radiološkim sustavima kao što su rendgenske snimke, magnetska rezonanca (MR) i kompjutorska tomografija (CT). Stražnji ventilirani dio pogodan je za odvod tekućine.

11.0.5665.00
11.0.5666.00
11.0.5667.00
11.0.5674.00
11.0.5673.00


Pojas za fiksaciju zapešća s magnetskom trakom
Pojas za fiksaciju gležnja s magnetskom trakom
Pojas za fiksaciju abdomena s magnetskom trakom
Pojas za fiksaciju gležnja s jednom kopčom
Pojas za fiksaciju zapešća s kopčom



Komplet za terapiju kisikom, 2 litre




Težina boce: 2,75 kg
Komplet za terapiju kisikom, 3 litre




boce: 3,65 kg

Komplet za terapiju kisikom, 5 litara





boce: 6,90 kg
Komplet za terapiju kisikom, 10 litara





Komplet uključuje: ` praznu bocu zapremine 2 l, ` reducirajući ventil, ` ovlaživač, ` maske za odrasle i djecu s crijevima.
Boca za kisik, 2 litre, prazna
Komplet uključuje: ` praznu bocu zapremine 3 l, ` reducirajući ventil, ` ovlaživač, ` maske za odrasle i djecu s crijevima, ` kolica za bocu.
Boca za kisik, 3 litre, prazna
Reducirajući ventil s protokomjerom za bocu za kisik

boce: 10,60 kg Kolica za bocu za kisik od 3, 5 ili 10l
Komplet uključuje: ` praznu bocu zapremine 5 l, ` reducirajući ventil, ` ovlaživač, ` maske za odrasle i djecu s crijevima, ` kolica za bocu.
Boca za kisik, 5 litara, prazna
Komplet uključuje: ` praznu bocu zapremine 10 l, ` reducirajući ventil, ` ovlaživač, ` maske za odrasle i djecu s crijevima, ` kolica za bocu.
Boca za kisik, 10 litara, prazna
Kolica u bijeloj boji na kojima stoji i vozi se boca za medicinski kisik.

Ovlaživač za boce za kisik

Komplet za kisik s maskom i cjevčicom

Punjenje boca Bocu možete napuniti u ovlaštenim punionicama naših partnera: MESSER UTP
21315 Dugi Rat, Industrijski put 8 tel. 021/734-880
51000 Rijeka, Liburnijska 3 tel. 051/685-300
44320 Kutina, Slavonska 6 tel. 044 /680-811
43283
Kaniška Iva, Ribnjaci tel. 034/431-062
35000
Slavonski Brod, Dr. M. Budaka 1 tel. 035/441-171
31000 Osijek, Poljski put 1 tel. 031/330-500
10290 Zaprešić, Industrijska ulica 1 tel. 01/3350-777
PULA
Svetog Polikarpa 4
Tel. (052) 214 886, Fax (052) 215 056
ZAGREB (Buzin) Bani 96
Tel. (01) 6608 213 Fax (01) 6608 215
UMAG
Ungarija bb
Tel. (052) 741 055, Mob. (098) 217 538
SISAK (Kisikana d.o.o.)
Stjepana i Antuna
Radića 17, Sisak 44000
Tel. (044) 534 852, Fax (044) 534 851
Novamed Expert 9F-5B koncentrator kisika
Šifra
9F-5B
Kompaktan i lagan koncentrator kisika s kapacitetom od 5 litara u minuti. Čistoća kisika iznosi više od 90%, čak i pri protoku od 5 litara na minuti. Mrežasti filtri imaju vijek trajanja od otprilike 75009000 sati, ovisno o uvjetima okoliša.
Tehničke karakteristike:
• Napajanje: 220V/50Hz | Ulazna snaga: 400VA
• Razina buke manja od 52 dB
• Izlazni tlak: 40-70 kPa
• Protok kisika: 0-5 L/min.

• Uređaj ima ugrađeni LCD zaslon s funkcijom tajmera.
• Zračni filter ulaznog zraka jednostavan je za čišćenje.
• Kompresor precizne izrade temeljen je na njemačkoj tehnologiji te ima vijek trajanja od više od 30.000 sati.
• Minimalno vrijeme rada: 30 minuta
• Bruto/netto težina: 20,5/17,5 kg
• Dimenzije: 48 × 40 × 63 cm
Koncentrator kisika Yuwell 8F-5A
8F-5A
5%
Yuwell 8F-5A koncentrator kisika namijenjen je podjednako uporabi u zdravstvenim ustanovama i za kućnu uporabu. Omogućuje visoku koncentraciju kisika izravno kroz nosnu kanilu. Kliničke studije dokumentiraju da su koncentratori kisika terapeutski ekvivalentni drugim sustavima za isporuku kisika.
Performanse:
• Opseg protoka: 0.5 ~ 5L/min
• Koncentracija kisika: 95.5% ~ 87%
• Maksimalni tlak:70 kPa
• Razina zvuka: 5L/min, tlak zvuka ≤ 54dB(A)
• Ulazna snaga: 350VA

Značajke:
• Bruto/neto težina (kg): 19/16.5
• Točnost mjerenja pulsa: ± 5%
• Težina: 16.5 kg
• Minimalno radno vrijeme: 15 minuta
• 47.5 cm x 33 x 58.5 cm
Prijenosni koncentrator kisika SPIRIT-3
OC10 Koncentrator kisika Šifra
Šifra
OC10
Model OC10 uređaj je koji proizvodi 93±3% čistog kisika koristeći okolni zrak koji sadrži 21% kisika. OC10 koncentrator kisika omogućava protok kisika do 10 litara u minuti, pri visokom tlaku i velikoj brzini. Osigurava da kisik dospijeva do pacijenta uz visoki protok bez smanjenja čistoće, čak i pri korištenju dugih produžnih kanila.
SPIRIT-3
Prijenosni koncentrator kisika SPIRIT-3 je kompaktan i učinkovit medicinski uređaj koji omogućuje pacijentima s respiratornim problemima da jednostavno i pouzdano dobivaju kisik.
Tehničke karakteristike:
• Tih rad, mala težina i kompaktnost - ovaj uređaj omogućuje očuvanje aktivnog načina života zahvaljujući tihoj, energetski štedljivoj i maloj konstrukciji.

• Pulsirajući protok - omogućuje učinkovito djelovanje u 4 različita načina rada.
• Praktičnost - uključena je torbica za nošenje uređaja.
• Jednostavno upravljanje - zaslon omogućuje jednostavno rukovanje, a sustav alarma brine o sigurnosti korisnika.
Koncentrator kisika s alarmom uz protok kisika od 1 do 10 l/min i funkcijom inhalacije
Šifra
8F-10/8F-10W
5%
8F-10W koncentrator kisika napravljen je od materijala visoke kvalitete što osigurava njegov siguran i pouzdan rad. U potpunosti je zaštićen plastičnom vanjskom oplatom koja ga čini idelanim za lako održavanje i čišćenje nakon uporabe. Upravljačka ploča postavljena je pod kutom koji omogućava jednostavno korištenje. 8F-10 varijanta - dolazi bez funkcije inhalacije.
Značajke:
• čistoća kisika od 87% do 95,5% uz podesivi protok kisika u razini od 1 do 10 l/min
• alarmni sustav s prekidom napajanja
• alarm previsokog ili niskog tlaka,
• ventil za smanjenje tlaka,

• zaštita rada kompresora,
• male dimenzije i težina,
• niska potrošnja energije,
• omogućuje visoku koncentraciju kisika za kućnu i profesionalnu terapiju.
• funkcija inhalacije
Performanse:
• Primjena: medicinska, kućna njega
• Konfiguracija: na kotačićima, prijenosni
• Volumen: 10 l (2,64 gal)
• Tlak kisika: 9 psi
• Razina buke: < 45 dB
• Snaga: 500 W
• Potrošnja energije: 500 W

Yuwell YH-550 auto CPAP uređaj za liječenje apneje u snu

YH-550 auto CPAP uređaj je s ugrađenim grijanim ovlaživačem. Dolazi s monokromatskim zaslonom koji je jednostavan i pregledan. Funkcijama ovog uređaja upravlja se putem rotirajuće tipke. Podaci o pacijentu pohranjuju se na uključenu micro SD karticu, a softver za interpretaciju podataka može se preuzeti s kartice. Osnovna analiza podataka može se pregledati izravno na uređaju. Uređaj je opremljen potpuno novim visokoučinkovitim motorom koji radi tiho i točno prati protok zraka.
Značajke Yuwell YH-550 auto CPAP uređaja:
• Wi-Fi funkcija
• Visokoučinkoviti motor
• Dizajn zračnog kanala bez spoiler-a – precizno prati signal protoka zraka i istovremeno smanjuje buku
• Patentirani Micro Airflow Laminar Flow Tube – opremljen naprednim senzorima za tlak i protok, točno prikuplja podatke o tlaku i protoku, te kontrolira u stvarnom vremenu
• Foc kontrolni algoritam – algoritam za povratnu propagaciju koji u stvarnom vremenu kompenzira curenje zraka
• Jasni podaci o liječenju – informacija o terapiji jasno je prikazana na 3,5-inčnom zaslonu
• Jednostavno upravljanje gumbima – jednostavna kombinacija dva gumba
• Tip »Lock&Lock« za spremnik za ovlaživanje
Značajke Yuwell YH-550 auto CPAP uređaja:
• Način liječenja: CPAP/Auto CPAP
• Raspon tlaka: 4~20 cmH2O
• Točnost tlaka: ±5 cmH2O
• Razina buke: ≤28dB
• Učinkovit ovlaživač: Da
• Preostali tlak visokog tlaka: Ne
• Preostali curenje: Da
• Kompenzacija curenja: Da
Auto CPAP uređaj za liječenje apneje u snu
• Podešavanje nadmorske visine: Da
• Upravljanje podacima: Da
• Alarm: alarm za pad maske
• Napon: 100-240V, 50-60Hz DC 24V
• USM sustav za zrak: ultra-tihi sustav za zrak
• PCM: tehnologija uklanjanja buke
• Tehnika samopodešavanja frekvencije 3A

Aparat za upuhivanje zraka, CPAP (Continuous positive airway pressure) se koristi kod težih slučajeva opstruktivnih apneja. Vrlo djelotvoran uređaj. Parametri spavanja se spremaju na SD karticu. Sadrži LCD zaslon. Dostupne su četiri metode smanjenje razine buke.
Tehničke karakteristike:
• Način liječenja Auto CPAP;
• Raspon tlaka 4-20 hPa; preciznost +/- 0,5 hPA;
• Snaga 100-240V,50-60Hz DC 24V.
• Radni tlak 4-20 cm H2O/hPa (moguća prilagodba po 0,5 cm H2O/hPa);
• Protok zraka 0-130 l/min s dopuštenim odstupanjem od +/- 5 l/min;
• Dimenzije 270 x 135 x 100 mm;
• Težina 1,56 kg
• Uključen ovlaživač
Yuwell YH-820 BiLevel PAP uređaj za liječenje apneje u snu

YH-820 BiLevel uređaj namijenjen je liječenju sindroma apneje i hipopneje u snu kod pacijenata težih od 30 kg. Namijenjen je podjednako za kućnu ali i upotrebu u bolničkim uvjetima. Spremnik za vodu namijenjen je za korištenje od strane jednog pacijenta u kućnom okruženju, dok je u bolničkim ili institucionalnim uvjetima predviđeno njegovo ponovljeno korištenje.
BiLevel YH-820 PAP uređaj posjeduje sljedeće značajke:
• Wisdom Humidifying: Nakon aktiviranja ove funkcije, uređaj će automatski ovlažiti zrak (ovisno o uvjetima u okolini).
• Zvučni podsjetnik: Uređaj će vas obavijestiti kada se primijeti abnormalno curenje zraka.
• FPS Razina (FPS Level): Kod rada na FPS razini, disanje postaje ugodnije jer se smanjuje otpor pri izdahu, a povećava udobnost pri udahu. Postoje 4 FPS razine, pri čemu je razina 0 isključena, a razina 3 najviša. Što je viša FPS razina, to će vaš proces disanja biti ugodniji.
• Filter Podsjetnik: Obavijest za promjenu filtra.
• Pozadinsko svjetlo: Podesiva jačina pozadinskog svjetla, s rasponom od 0-100%.
• Datum i Vrijeme: Postavite datum i vrijeme za prikaz na ekranu.
• Alarm za sat: Aktivirajte ovu funkciju kako biste dobili obavijest u određenom vremenskom razdoblju.
• Obnavljanje zadatih postavki: Ova funkcija briše podatke i vraća uređaj na tvorničke postavke
Značajke:
• Načini rada: CPAP, S, ST, T, VGPS
• Maksimalni tlak pri udahu (IPAP): 4-20 cm H2O (za S, T, ST, VGPS)
• Pozitivni tlak pri izdahu (EPAP): 4-20 cm H2O (za S, T, ST, VGPS)
• Postavke terapijskog tlaka (CPAP): 4-20 cm H2O
• Broj udisaja u minuti (BPM): 5-50 BPM, prilagodljivo u koracima od 1 BPM
• Omjer udaha - izdisaja (I/E): Podesivo, od 10% do 70%
• Volumen zraka: 50-1500 ml (samo za VGPS način rada)
• Ovlaživač: 6 postavki
• Razina buke: 43 dB
• Dimenzije: 28,5 x 15,5 x 12,5 cm
• Težina: 1,5 kg
Apneja alarm za bebe i djecu
02.7.4183.00 BC200 - 1 senzor
02.7.3856.00 BC210 - 2 senzora 02.7.3374.00 BC230 - 3 senzora

Uređaj za praćenje disanja djeteta (APNEJA alarm). Dostupan u varijanti s 1, 2 i 3 senzora. Poseban softver prati gibanja povezana s disanjem, a alarm će se oglasiti ako disanje nije detektirano više od 20 s, ako su detektirana svega 3 udisaja unutar 20 s ili ako disanje postane vrlo plitko unutar 30 s. Ako se unutar 10 s rada alarma ne detektira pokret, alarm će nastaviti raditi kako bi se za dijete pobrinuo roditelj.
Flaem Aspira 40Profesionalni kirurški aspirator
Šifra TOWASGO40
Flaem Aspira 40 profesionalni je kirurški aspirator namijenjen za upotrebu u zdravstvenim ustanovama poput bolnica, klinika i kirurških centara. Također je indiciran za kućnu terapiju faringealne aspiracije. Može se postaviti na opcionalno postolje i opremiti udobnom papučicom za intermitentnu upotrebu.


Profesionalni prijenosni aspirator na baterije Aspira Go | FLAEM
Šifra
Opis
TOW000634 Aspira Go 20 - usisni protok od 30 l/min.
TOW000635 Aspira Go 30 - usisni protok od 30 l/min.
TOW004400 Torba za Aspira Go
Model Aspira Go je profesionalni prijenosni aspirator, na baterije, za medicinsku i kiruršku upotrebu u zdravstvenim ustanovama, za kućnu njegu i za sukciju ždrijela. Proizveden je u skladu sa EN ISO 10079-1 standardom a deklarirani protok ispitan je i potvrđen od strane TÜV Rheinland. Opremljen je hidrofobnim antibakterijskim visokoučinkovitim filterom kojeg je potrebno zamijeniti svaka 2 mjeseca kada ga upotrebljava jedna osoba.
Tehničke karakteristike:
• Napon: 12V
• Dimenzije uređaja: 36(D) x 14(Š) x 27(V) cm
• Težina: 2,5 kg
• Vrijeme korištenja: 30 minutes ON/ 30 minutes OFF
• Aspiracija: Jak vakuum/jak protok
Šifra
TOW000637
Aspira Plus je profesionalni kirurški aspirator, namijenjen medicinskoj i kirurškoj upotrebi. Pogodan je za korištenje kako u zdravstvenim ustanovama kao što su bolnice, tako i za kućnu njegu. Aspira Plus aspirator u skladu je s normom EN ISO 10079-1. Deklarirani protok od 20 l/min je testiran i potvrđen od strane TÜV Rheinlanda. Držač za bocu može se postaviti na desnu ili lijevu stranu
uređaja, a sadrži bocu od jedne litre na kojoj se nalazi gradacija. Ova boca i silikonske spojne cijevi mogu se sterilizirati radi optimalne higijene. Uređaj ima hidrofobni antibakterijski filter visoke učinkovitosti. Kućište je izrađeno od vrhunske plastike, što osigurava robusnost pri intenzivnoj upotrebi, a istovremeno smanjenu težinu radi lakšeg transporta zahvaljujući praktično integriranoj ručki.
Tehničke karakteristike:
• Patentirani sustav ASPICOMFORT za preciznu kontrolu razine aspiracije
• Patentirani držač za posude: fleksibilan, stabilan, jednostavan za čišćenje
• Boca od 1 litre (1 uključena)autoklavabilna
• Protok od 20 l/min


• Podesiva razina vakuuma: Otprilike -0.10 do -0.80 bara (točnost razreda 2,5)
• Max. Protok zraka: Otprilike 20 l/min
• Razina buke (na 1 m): Otprilike 63 dB (A)
• Vrijeme punjenja baterije: 7 sati (minimalno)
• Podesiva razina vakuuma
• Tih rad - 56dB
• Posuda i cijevi se mogu sterilizirati
• Cijevi izrađene od silikona

• Antibakterijski filter
• Napajanje 220V/50 Hz
• Dimenzije uređaja: 325 x 120 x 235 mm / težina 2,4 kg

Sadrži:
• Posudu od 1000 ml
• Filter
• Crijevo



ROSSMAX aspirator V3

Idealan za njegu pacijenata poslije traheotomije, manje operativne zahtjeve te za postoperativnu bolničku i kućnu njegu. Pumpa visokih performansi pruža vakuum od -550 mmHg i protok od 16 litara/min. Zaštitni ventil protiv prelijevanja plus antibakterijski filter i intuitivan dizajn uređaja spriječavaju vraćanje tekućine i ulazak vanjskih onečišćivača u pumpu. Držač cijevi i pretinac za pribor omogućuju jednostavno spremanje.
Tehničke karakteristike:
• Visok vakuum / niski protok
• Maksimalni vakuum (na ulazu pumpe): -73 kPa/ -550 mmHg
• Maksimalni usisni protok (na ulazu pumpe): 16 l/min
• Adapter, ulaz: AC 100-240V, 50/60Hz
• Adapter, izlaz: DC 12V 2.0A
• Zapremnina sabirnog spremnika: 1.4L (Polikarbonat, PC)
• Potrošnja struje: ≤ 24W
ROSSMAX aspirator V7 s punjivom baterijom
ROSSMAX aspirator V5

Idealan za njegu pacijenata poslije traheotomije, manje operativne zahtjeve te za postoperativnu bolničku i kućnu njegu. Pumpa visokih performansi pruža vakuum od -600 mmHg i protok od 30 litara/min. Zaštitni ventil protiv prelijevanja plus antibakterijski filter i intuitivan dizajn uređaja spriječavaju vraćanje tekućine i ulazak vanjskih onečišćivača u pumpu. Držač cijevi, posuda za odlaganje cijevi i pretinac za pribor omogućuju jednostavno spremanje. Sveobuhvatna nadzorna ploča s ergonomskim kutem gledanja osigurava nesmetan rad. Jednostavno otvaranje poklopca na gumb.
Tehničke karakteristike:
• Visok vakuum / visoki protok
• Maksimalni vakuum (na ulazu pumpe): -80 kPa/ -600 mmHg
• Maksimalni usisni protok (na ulazu pumpe): 30 l/min
• Napajanje: AC 100-120V, 50/60Hz ili AC220-240V, 50/60Hz
• Zapremnina sabirnog spremnika: 1.4L (Polikarbonat, PC)
• Potrošnja struje: ≤ 55W
Idealan za njegu pacijenata poslije traheotomije, manje operativne zahtjeve te za postoperativnu bolničku i kućnu njegu. Pumpa visokih performansi pruža vakuum od -600 mmHg i protok od 30 litara/min. Zaštitni ventil protiv prelijevanja plus antibakterijski filter i intuitivan dizajn uređaja spriječavaju vraćanje tekućine i ulazak vanjskih onečišćivača u pumpu. Držač cijevi, posuda za odlaganje cijevi i pretinac za pribor omogućuju jednostavno spremanje. Sveobuhvatna nadzorna ploča s ergonomskim kutem gledanja osigurava nesmetan rad. Jednostavno otvaranje poklopca na gumb.

Boca za aspiraciju


Antibakterijski filter komplet za aspirator V3, V5 i V7

Cijev za aspiratore V3, V5 i V7

Šifra Opis
07.5.0859.00 F18
07.5.2100.00 F36
Prijenosni uređaj za usisavanje pri manjim kirurškim zahvatima i post-traheotomiji, za osobnu upotrebu. Idealan za postoperativnu njegu kod kuće. Lagano kućište sa zaštitom od udaraca. Jednostavno prenošenje i održavanje. Opremljen bocom zapremnine 1 litre koja se može sterilizirati, s prestrujnim ventilom. Opremljen regulatorom snage usisavanja i mjeračem vakuuma.

F18 | Tehničke karakteristike:
• Max. snaga vakuuma: (bar/Hgmm) 0,75/563
• Snaga usisa (l/min): 23
• Zapremnina boce: 1×1 l
• Potrošnja: 127 W
• Napajanje: 230 V 50-60 Hz
• Dimenzije (cm): 26×18×22
• Težina (kg): 2,5

F36 | Tehničke karakteristike:
• Max. snaga vakuuma: (bar/Hgmm) 0,8/600
• Snaga usisa (l/min): 37
• Zapremnina boce: 1×1 l
• Potrošnja: 157 W
• Napajanje: 230 V 50-60 Hz
• Dimenzije (cm): 26×18×22
• Težina (kg): 2,5
Šifra Opis
07.5.1079.00 F31
Prijenosni uređaj za usisavanje pri manjim kirurškim zahvatima; profesionalna upotreba. S jakim dvoklipnim motorom. Idealan za postoperativnu njegu kod kuće. Lagano kućište od ABS plastike sa zaštitom od udaraca, jednostavno prenošenje. Opremljen bocom zapremnine 1 litre koja se može sterilizirati, s prestrujnim ventilom.
Šifra Opis
07.5.2715.00 F20
07.5.2364.00 F40
Prijenosni uređaj za usisavanje pri manjim kirurškim zahvatima, za profesionalnu upotrebu. Idealan za postoperativnu njegu kod kuće. Lagano kućište od ABS plastike sa zaštitom od udaraca. Opremljen bocom zapremnine 1 litre koja se može sterilizirati, s prestrujnim ventilom. Opremljen regulatorom snage usisavanja i mjeračem vakuuma.

F20 | Tehničke karakteristike:
• Max. snaga vakuuma: (bar/Hgmm) 0,75/563
• Snaga usisa (l/min): 23
• Zapremnina boce: 1×1 l
• Potrošnja: 127 W
• Napajanje: 230 V 50-60 Hz
• Dimenzije (cm): 35×21×25
• Težina (kg): 3,5
F18 | Tehničke karakteristike:
• Max. snaga vakuuma: (bar/Hgmm) 0,75/563
• Snaga usisa (l/min): 30
• Zapremnina boce: 1×1 l
• Potrošnja: 5 W
• Napajanje: 110 V 50-60 Hz
• Dimenzije (cm): 45×15×28
• Težina (kg): 4
Šifra Opis
07.5.0489.00 F60
07.5.2713.00 F36
07.5.2714.00 F100
Prijenosni aspirator za profesionalnu upotrebu, s jakim dvoklipnim motorom (velika snaga vakuuma, regulacija i kontrola pomoću mjerača vakuuma). Kućište od ABS plastike sa zaštitom od udaraca. Priključak za cijev, 2 silikonske cijevi, 1 filter i 1x usisna kanila (sterilna, jednostruko pakirana). Četiri antistatička kotačića (dva s kočnicom). Dvije boce zapremnine 2 l (mogu se sterilizirati u autoklavu) - svaka boca opremljena je dvostrukim sigurnosnim ventilom. Zasebni dvostruki spremnik za otjecanje. Sve modele aspiratora moguće je nabaviti i u kompletu s papučicom za kontrolu aspiracije ili nabaviti papučicu zasebno.

Tehničke karakteristike:

F36 | Tehničke karakteristike:
• Max. snaga vakuuma: (bar/Hgmm) 0,8/600
• Snaga usisa (l/min): 37
• Zapremnina boce: 1×1 l
• Potrošnja: 157 W
• Napajanje: 230 V 50-60 Hz
• Dimenzije (cm): 26×18×22
• Težina (kg): 2,5



Šifra Opis
LTA260 2,2 | 16l
LTA270 2,3 | 40l LTA280 2,5 | 16l
Prijenosni aspirator za profesionalnu uporabu koji se može napajati putem obične utičnice, 12V priključka u autu ili punjive baterije. Uključeni dodaci: posuda, poklopac za posudu sa zaštitom od preljevanja, filter, komplet silikonskih cijevi, priključak za cijev, usisna sonda, kabel za utikač u automobilu (LTA280).
Maksimalni usisni protok 16 l/min 40 l/min
Maksimalno usisavanje



Profesionalni prijenosni aspirator New Askir
Dizajniran prvenstveno za ambulante i bolničke odjele, ali i za male kirurgije, postoperativnu terapiju. Napaja se iz unutarnje punjive baterije, 230 V utičnice ili utičnice za automobil. Izdržljiva, bezuljna, snažna usisna pumpa bez održavanja. Snažna crpka osigurava vrlo brz odaziv i stvaranje vakuuma. Osim toga, aspirator ASPIMED 1.9 ima LED lampu koja osvjetljava radnu površinu.
Tehničke karakteristike:
• Visok vakuum/ visok protok.
• Najveći aspiracijski protok 30 l/min.
• Podesiv najveći vakuum: 0 do -0,85 bar.

• Razina buke: 61 dBa.
• Kontinuiran rad: 45 min.
• Punjiva baterija: 12 V 4Ah.
• Sigurnosno LED svjetlo.
• Dimenzije: 380x135x260 mm
• Težina: 4,6 kg.
Prijenosni aspirator, napajanje: 12 V DC. Za aspiraciju nosa, usta i traheje. Izrađen od plastičnog materijala otpornog na toplinu, s izolacijom. Dodaci: komplet cijevi, priključak za sondu, sonda za aspiraciju CH20, antibakterijski filter, boca za aspiraciju.
Tehničke karakteristike:
• Max. snaga vakuuma (bar/Hgmm): 0,75/563
• Snaga usisa (l/min): 25
• Zapremnina boce: 1×1 l

• Potrošnja: 40 W
• Napajanje: 12 V DC
• Dimenzije (cm): 35×21×18
• Težina (kg): 3

Jednostavan, lagan i kompaktan aspirator, namjenjen medicinskoj i osobnoj upotrebi. Zbog svoje male veličine, lako stane u torbu, pogodan za patronažu i kućnu njegu. Višekratno upotrebljiva ručka za usisavanje omogućuje stvaranje vakuuma jačeg do 600 mmHg. Spremnik od 300 ml. Na uređaj se može priključiti bilo koji standardni, sterilni usisni kateter.
Antistatični kotačići, dvije kočnice. Podesiva ručka za transport. Uključeni dodaci: 2 polikarbonatne posude (koje se mogu sterilizirati u atoklavu) s ventilom protiv prolijevanja, 2 polikarbonatna priključka, 1 set silikonskih cijevi, 2 komada 99% hidrofobnih antibakterijskih filtera.
Tehničke karakteristike:
• Kapacitet: 2l posuda
• Napajanje: 230V / 50-60Hz
• Apsorpcijska snaga: 300 VA

• Maksimalni vakuum: 0 ÷ 0,90 bar (0 ÷ -90 kPa)
• Maksimalni protok: 60 l / min
• Kabel za napajanje: 2 m
• Osigurač: 250V T 2,5A
• Razina buke: 54 dBA
• Dimenzije: 470(d) x 580(š) x 560 ÷ 730 mm
• Težina 15 kg
Plastična boca s poklopcem | Fazzini
Antibakterijski filter za aspiratore | Fazzini Komplet cijevi (kratka i duga) za F-18/ F-36 / F-20 / F-40 | Fazzini
Usisni kateteri za profesionalne aspiratore
Rezervni dijelovi za aspiratore Aspivac / Aspimed | MORETTI





ChoiceMMed MD300K2 pulsni oksimetar sa sondom za odrasle
Prijenosan, kompaktan i pouzdan pulsni oksimetar MD300K2, jednostavan za ko rištenje zbog intuitivnog upravljačkog su čelja i lakoće rukovanja. Sadrži 127 memo rijskih mjesta za zasebne pacijente te ima mogućnost pohranjivanja očitanja mjere nja do 72 sata. U paketu je uključena son da za odrasle.
Tehničke karakteristike:
• Raspon mjerenja (SpO2): 70-100%
• Gradacija (SpO2): 1%

Slika je informativna. Pulsni oksimetar dolazi bez postolja.
• Preciznost mjerenja (SpO2): 70-100%: ±2%, 0-69% nije definirano
• Raspon mjerenja (puls): 30-250 otkucaja u minuti
• Gradacija (puls): 1 bpm
• Prikaz perfuzijskog indeksa: 0.1%-20%
• Preciznost (perfuzijski indeks): 0,1%-1,0%, ±0,2%; 1,1%-20%, ±20%
• Zaslon: 2.4« TFT ekran visoke rezolucije
• Parametri sučelja: SpO2, Puls, grafičko očitanje pulsa, PI (pletizmogram)
• Prijenos podataka: USB
• Dimenzije uređaja: 143 x 67 x 36mm ±3 mm
• Težina uređaja (bez baterija): 140 ±10g (bez baterija)
• Napajanje: 3 AA alkalne baterije
• Operativno vrijeme uređaja na baterijama do 10 sati u kontinuitetu
• Radni uvjeti: 0°C do 40°C, rel. vl. zraka: ≤80%, bez kond., tlak zraka 86kPa do 106 kPa
• Uvjeti skladištenja: -20°C do +70°C, rel. vl. zraka: ≤93%, bez kond., tlak zraka 86kPa do 106 kPa
• Zaštita od strujnog udara: Unutarnja oprema za napajanje i oprema Klase II, tip BF (SpO2 sonda)
• Zaštita od prodiranja vode: IPX1
Šifra Opis
ChoiceMMed MD300M oksimetar za intenzivnu uporabu | sa sondom za odrasle
Prijenosan, kompaktan i pouzdan pulsni oksimetar, jednostavan za korištenje zbog intuitivnog upravljačkog sučelja i lakoće rukovanja. Sadrži 127 memorijskih mjesta za zasebne pacijente te ima mogućnost pohranjivanja očitanja mjerenja do 72 sata. Uz uređaj dolaze računalni program za analizu i pregled podataka te USB kabel za povezivanje na računalo. U paketu je uključena sonda za odrasle.
Tehničke karakteristike:
• Raspon mjerenja (SpO2): 70-100%
• Gradacija (SpO2): 1%

• Preciznost mjerenja (SpO2): 70-100%: ±3%, 0-69%: nije navedeno
• Raspon mjerenja (puls): 30-235 otkucaja u minuti
• Gradacija (puls): 1 bpm
• Preciznost mjerenja (puls): ±2bmp ili ±2%
• Zaslon: 2.8« TFT ekran
• Parametri sučelja: SpO2, Puls, grafičko očitanje pulsa, PI (pletizmogram)
• Prijenos podataka: USB
• Dimenzije uređaja: 125 x 60 x 30mm
• Težina uređaja (bez baterija): 195 g
• Napajanje: 3 AA alkalne baterije
• Operativno vrijeme uređaja na baterijama 16 sati u kontinuitetu
• Radni uvjeti: 0°C do 40°C, rel. vl. zraka: ≤80%, bez kond., tlak zraka 86kPa do 106 kPa
• Uvjeti skladištenja: -20°C do +70°C, rel. vl. zraka: ≤93%, bez kond., tlak zraka 86kPa do 106 kPa
• Zaštita od strujnog udara: Unutarnja oprema za napajanje i oprema Klase II, tip BF
• Zaštita od prodiranja vode: IPX1
M-50C006CS09 za novorođenčad (pedijatrijska) za pulsni oksimetar MD300M i MD300K2
M-50B008CS09 za djecu za pulsni oksimetar MD300M
M-50E012CS09 za odrasle za pulsni oksimetar MD300M



PRVI NA SVIJETU - pulsni oksimetar s tehnologijom pregleda arterija | ROSSMAX

Prvi pulsni oksimetar s tehnologijom pregleda arterija (analiza vaskularne dobi) uz mjerenje zasićenosti kisika u krvi (SpO2) i pulsa. Pulsni oksimetar se koristi za odrasle i djecu starije od 3 godine u bolnicama, klinikama i/ili kod kuće. Koristi tehnologiju pregleda arterija (ACT). Trenutna očitanja SpO2, pulsa i stanja arterija u jednoj minuti. Oblik koji umanjuje intenzitet ambijentalnog svijetla. Biokompatibilna zaštita. Indikator jačine pulsa. Vidljiv i glasan alarm. Dvosmjerni, dvobojni OLED zaslon. Traka za vezanje.
Tehničke karakteristike:
• Mjerni raspon: 35%-99% (rezolucija 1%)
• Preciznost: 70%-99% +-2%; ispod 35-69%:neodređeno
• Optički senzor: crveno svjetlo (valna duljina je 660 nm), infracrveno svjetlo (valna duljina je 905/880 nm)
Puls
• Mjerni raspon: 30bpm-250bpm (rezolucija je 1 bpm)
• Preciznost: +-3bpm
• Napajanje: AAA x 2 (alkalna)
• Trajanje baterije: kontinuirano 16 sati s dvije alkalne baterije
• Dimenzije: 63,5x34x35 mm
• Težina: oko 37g (bez baterija)
• Zaštita: tip BF
• IP klasa: IP22 zaštita od prodiranja vode i čestica
Pulsni oksimetar za odrasle i djecu Vitammy O2 Connect pulsni oksimetar
VITAMMY O2 Connect je medicinski pulsni oksimetar s OLED zaslonom koji prikazuje zasićenje kisika u krvi (SpO2) i puls, stupčasti i valni grafikon pulsa.
Tehničke karakteristike:

• Višefunkcijski OLED zaslon s mogućnošću okretanja prikaza
• Prikaz zasićenja kisika u krvi (SpO2), pulsa, stupčastog grafikona (snaga pulsa) i valnog grafikona pulsa (tijek pulsa)
• Zvučni signal pulsa
• Medicinski certifikat CE0123
• Vrlo jasan, svijetli i dvobojni OLED zaslon
Pulsni okismetar za djecu | CONTEC Šifra
Pouzdan pulsni oksimetar po vrlo povoljnoj cijeni. Služi za mjerenje zasićenosti krvi kisikom i pulsa. Prijenosan i vrlo praktičan.
Tehničke karakteristike:

• Područje primjene: odrasle osobe, adolescenti, djeca
• SpO2 mjerni raspon: 70% - 100%
• Rezolucija: 1%

• Točnost mjerenja: 70% - 100%: ± 2%; 0% - 69%: nema definicije
• Raspon mjerenja brzine pulsa: 30 - 235 (250) bpm
• Rezolucija: 1 bpm
• Točnost mjerenja: 30 - 99 bpm: ± 2bpm 100 - 235 (250) bpm: ± 2%
• Vrsta zaslona: OLED
• LED Sonda: Crvena - Valna duljina 660±2nm; Snaga zračenja 1,8mW IR - Valna duljina 940±10nm; Snaga zračenja 2,0mW
• Parametri: SpO2, Puls, Grafički prikaz otkucaja srca
• Prikaz: 2 načina prikaza
• Dimenzija: 58 mm (D) * 32 mm (Š) * 34 mm (H)
• Težina: 50 g
• Zahtjev za napajanje: Dvije baterije od 1,5 V AAA; potrošnja manja od 30mA
Pulsni oksimetar namijenjen za djecu | Panda
Mjeri zasićenost krvi kisikom SPO2 i puls. Dolazi s dvije AAA baterije, torbicom, trakicom za nošenje oko vrata i zaštitnom silikonskom navlakom. S motivom slatke Pande kako bi bio simpatičan djeci.
Tehničke karakteristike: SpO2
• Raspon mjerenja: 70% - 100%
• Rezolucija: ±1%
• Preciznost mjerenja: 80% - 100%: ±2% 70% - 79%: ±3% 69%: nije definirano Pulse Rate
• Raspon mjerenja: 30 - 235bpm
• Rezolucija: ±1bpm
Pedijatrijski pulsni oksimetar u jedinstvenom izdanju. Šareno kućište oksimetra olakšava poticanje djeteta na obavljanje pregleda.

Tehničke karakteristike:
• Veličina zaslona: 160 x 80 px
• Dimenzije: 59 mm x 37 mm x 35 mm
• Težina: 50 g (s baterijama)
• Raspon mjerenjaSpO2: 0% 100% (rezolucija je 1%) | Preciznost: 70% 100% ±2% , ispod 70% nije specificirano.

• Preciznost mjerenja: 30 - 99bpm: ±2bpm 100 - 235bpm: ±2 % Ekran
• Tip: Dvobojni OLED ekran
• Prikaz parametara: SpO2, puls, pulsni graf, pletizmogram
• 4 različita prikaza
• Svjetlina: 10 razina osvjetljenja ekrana
• Alarm
• Raspon mjerenja PR: 30bpm 250bpm, (rezolucija je 1bpm) | Preciznost: ±2bpm ili ±2% (odabrati veću vrijednost
• Potrošnja energije: manje od 30mA
• Napon: DC 2.6V - 3.6V
• Napajanje: 2 x 1.5V AAA alkalna baterija



LITTMANN
Šifra
LITT-5627
LITT-5839
LITT-5623
LITT-5835
LITT-5622
LITT-5620
LITT-5621
LITT-5831
LITT-5832
LITT-5633
Visoka akustična osjetljivost i iznimne performanse kada se rade opće fizičke procjene. Podesiva dijafragma Dvostrano zvono moderniziranog dizajna koji je



Stetoskop KaWe Colorscop Duo
Šifra Boja
01.8.0348.01 crvena
01.8.0348.02 crna
01.8.0348.03 plava
01.8.0348.04 zelena
01.8.0348.05 žuta
01.8.0348.06 lila
01.8.0348.07 tirkizna
01.8.0348.08 pink

Kvalitetna kromirana glava
Membrana: Ø 43,8 mm. Y-cijev duljine 55 cm.
UP-7000 | Veterinarski Monitor Vitalnih Funkcija
Šifra
UP-7000
• 12,1-inčni TFT LCD kolor zaslon osjetljiv na dodir
• Rezolucija: 800 x 600 piksela
• Prikaz do 6 valnih oblika
• Parametri mjerenja: EKG, disanje, SpO2, NIBP, temperatura

• Visokokvalitetni 12,1-inčni TFT LCD kolor zaslon s grafičkim i numeričkim prikazom mjerenih parametara
• Mogućnost povezivanja na mrežu za praćenje Veliki kapacitet pohrane za grafikone i tablice
• Vidljivi i zvučni alarm, podesiv na 3 razine glasnoće
• Funkcija za pregled i modifikaciju donje i gornje granice praćenih parametara.
• Navigacijski gumb
• Raspon mjerenja za manje i veće životinje. 3-kanalni termalni pisač
sada lakše čistiti i održavati. Nova generacija materijala za izradu crijeva otpornija na ulja i alkohol. Promjer zvona za odrasle 4,3 cm, a za djecu 3,3 cm. Pet godina jamstva.








Profesionalni kardiološki stetoskop Rossmax EB-600
Poput Littmann modela. Akustički superosjetljiv. Napredna konstrukcija od nehrđajućeg čelika; dva izmjenjiva zvona; mekane slušalice. Uključena dodatna dijafragma. Bez lateksa.

PC-900vet | Veterinarski
Monitor Vitalnih Funkcija
Šifra
PC-900vet
• Veliki, svijetli LED zaslon: Jasna vidljivost krvnog tlaka, SpO2 i pulsa
• Kolor LCD: Prikaz pletizmograma za detaljnu analizu
• Točno mjerenje NIBP-a: Pouzdana mjerenja krvnog tlaka sa zaštitom od prekomjernog tlaka i funkcijom hemostat putem manžete

• Osjetljivo mjerenje SpO2 i pulsa: Precizno praćenje uz funkciju zvučnog signala
• Opsežna pohrana podataka: Pohrana do 12.000 mjerenja krvnog tlaka za pregled i analizu, podatke je moguće prenjeti na računalo
• Raznolik pregled podataka: Pregled povijesnih podataka u valnom obliku, popisu ili trend grafikonu
• Robusan alarmni sustav: Višerazinski zvučni i vizualni alarmi za kritične situacije
Stetoskop za mjerenje tlaka Rossmax EB-100
Šifra
Mekane slušalice. Glava stetoskopa koja ne hladi. Posebno dobro prilagođen za rad s tlakomjerima.

PC-900Bvet | Prijenosni
Monitor Vitalnih Funkcija
Šifra PC-900Bvet

• Konfiguracija: prijenosni, kompaktan
• Mjereni parametri: EtCO2, SpO2, RR i PR
• Primjena: intenzivna njega, hitna pomoć, veterina, transport, anestezija
• Opcije i pribor: USB
• Veličina zaslona: 3,5 inčni TFT zaslon
• Trajanje baterije: 10 sati
• Pulsni ritam: Maks.: 250 jedinica, Min.: 30 jedinica
• Razina kisika: Maks.: 100 %, Min.: 0 % Kompaktan dizajn idealan za korištenje kako u humanoj medicini tako i u veterini kod hitnih slučajeva, transporta i spašavanja na otvorenom. Primjenjiv je u anesteziologiji, respiratornoj medicini, intenzivnoj njezi i praćenju spavanja. Primjenjiv za intubirane i neinintubirane pacijente.
Šifra
01.3.0918.00
01.3.0918.01
Način prikaza: TFT LCD zaslon visoke rezolucije od 12’’ u boji. Može se koristiti za potpuno praćenje odraslih, djece i novorođenčadi. Jezici prikaza su kineski i engleski. (Dostupni jezici: francuski, njemački, talijanski, nizozemski, turski, itd.).

Postoji nekoliko načina prikaza koje možete izabrati, kao što je prikaz velikih znakova. Valni oblik i boja podataka mogu se postaviti. Memorija: pohranite i pregledajte 480 sati podataka o trendu i 40-sekundni holografski valni oblik. Zaslon prikazuje 7-odvodni EKG i niz EKG tragova. Anti-visokofrekventni kirurški uređaj, otporan na defibrilator (zadovoljava različite posebne zahtjeve). Koristi digitalnu Spo2 tehnologiju, koja ima snažnu zaštitu od smetnji i nisku sposobnost punjenja.
Tehničke karakteristike:

400 NIBP podataka može se pohraniti i pregledati. Umrežno : spojivo na središnju stanicu, druge nadzirane krevete i ažuriranje softvera. Način mrežnog povezivanja: žičane i bežične. Ugrađena SD kartica. U disk za pohranjivanje podataka i U disk za ažuriranje. Izlaz za podršku VGA video značajkama i podesivim LCD pozadinskim osvjetljenjem. Alarm s ljudskim glasom. Funkcija simultanog izlaza signala. Tri načina rada: praćenje, operacija i dijagnostika. Automatska analiza valnog oblika aritmije. Proračun koncentracije lijeka i titracija. Dvokanalna provjera temperature i signal u slučaju temperaturne greške. NIBP softver i hardver za dvostruku zaštitu od nadtlaka. Ugrađena punjiva litijska baterija za kontinuirano praćenje. Uređaj ima američki FDA i europski CE certifikat. Standardni parametri: EKG SPO2 NIBP RESP TEMP PR. Dodatni parametri: 2-IBP CO2. Sadržaj paketa: 1 - pinceta sPO2 za odrasle - EKG kabel - NIBP manžeta + produžna cijev - Kabel za napajanje - Senzor temperature - EKG elektrode - Baterija
01.3.0918.01 | s termalnim pisačem
Šifra
01.3.5376.00
Monitor vitalnih funkcija, namijenjen za upotrebu kod odraslih pacijenata, djece i novorođenčadi. Izvrstan uređaj, veoma jednostavan za korištenje.
Tehničke karakteristike:

Primjena: Kirurgija, intenzivna njega, hitna služba, opstetricija i ginekologija, pedijatrija. Ugrađena Litij-polimer baterija za sigurnije praćenje. Kompaktan i lagan dizajn. Uređaj je prenosiv, te je tako prikladan za korištenje na terenu te u zatvorenom prostoru. Shvatljivo i jednostavno korisničko sučelje. Zaslon: 2.8” (320x240px) LCD u boji, s crvenim i žutim LED. Motri sistolički (SYS) i dijastolički (DIA) krvni tlak, SpO2 i puls. Moguće podešavanje graničnih vrijednosti. Flash memorija, pohranjivanje 2.000 NIBP unosa i 78.000 SpO2 unosa. Prikladno i brzo dohvaćanje podataka, NIBP, SpO2, PR moduli.
Šifra
01.1.5773.00
Tehničke karakteristike:
• Jednokanalni EKG uređaj.
• Prijenosan uređaj s litijskom baterijom.
• Jedno punjenje je dostatno za 4 do 5 mjerenja.
• Automatski i ručni način rada.

• Detekcija spajanja elektroda i prikaz na zaslonu.
• Ugrađeni filteri: AC, EMG, DFT.
• Visoka rezolucija slike za ispis.
• Ugrađen termalni pisač.
Capno Cube Vet | Monitor disanja u veterini
Šifra
Capno Cube Vet
• Prati razinu EtCO2 i prikazuje je u realnom vremenu
• Kapnogram u roku od 15 sekundi
• Za praćenje intubiranih životinja
• 6 sati rada s Li-ion baterijom
• Veliki, jasno vidljiv zaslon
• Prikladan za pse, mačke i druge životinje
• CE certifikat
VET ultrazvučni dopler
Šifra
01.3.5379.00


Ultrazvučni dopler za pregled krvotoka kod životinja. Osim za opći pregled, prikladan je za kontinuirano praćenje otkucaja srca za vrijeme operacije, mjerenje sistoličkog tlaka te provjeru cirkulacije nakon operacije.
Paket sadrži:
Doppy VET uređaj, ultrazvučnu sondu 8 MHz, punjač za baterije, 3 pojasa za učvršćivanje senzora, ultrazvučni gel i torbicu.
Čitač mikročipa za životinje
Šifra
12.0.5850.00

Za brzo i lako očitanje mikročipova u životinja, jednostavan za korištenje. Podržava ISO11784/5 FDX-B i ID64 standarde.
Tehničke specifikacije:
• Kompatabilan sa Scanner Angel programom
• Memorija: 1.000 podataka
• Udaljenost čitanja: Ušna markica - 20 cm
• Mikročip - 10 cm
• Zvučni signal: Zvučni signal za vrijeme očitanja
• Zaslon: 128x64 OLED 1.54«
• Povezivanje: USB
• Napajanje: 3 x AA baterija
• Radna temperatura: -30°C - 50°C
• Veličina proizvoda: 250x126x31 mm
• Neto težina: 160 g
• Oprema: Kutija, USB kabel
Šifra
SP-20 Vet
Lepu Medical SP-20 Vet ručni pulsni oksimetar može mjeriti SpO2, PI (indeks perfuzije), valni oblik i PR (pulsna frekvencija). Senzor se jednostavno postavlja na jezik, uho, šapu ili rep životinje. S 3,5-inčnim automatski rotirajućim TFT zaslonom i velikom pohranom podataka, jednostavan je i brz za korištenje.

• Prikladan za mjerenja kod životinja različite veličine
• Integrirana litijeva baterija, do 18 sati rada
• Kontinuirani 24/7 sustav praćenja
• S velikim kapacitetom pohrane podataka (500 sati za podatke SpO2) i dohvatom podataka u bilo kojem trenutku
• Automatska orijentacija zaslona (horizontalna/vertikalna)
• Integrirani stalak za praktično postavljanje uređaja
• Zvučni i vizualni alarmni signali
Šifra
07.6.5373.00

Mali, prijenosni veterinarski pulsni oksimetar s niskom potrošnjom energije i vanjskim senzorom. Funkcija alarma. Mogućnost 24-satnog praćenja. Povezivanjem na računalo, podaci se mogu pohraniti, analizirati i ispisati. Online nadziranje preko računala. Ugodna hvataljka sa senzorom koja ne smeta životinji prilikom dužeg nošenja. Mjerni raspon: 30 - 250 bpm i 0 - 100% SpO2. LCD aslon 1.8 ». Napajanje: 2 AA alkalne baterije. Prikaz parametara na zaslonu: SpO2, otkucaji srca, dijagram, krivulja pulsa. Dimenzije: 35x20x15 cm.
Wellmed EASY TOUCH GU
Šifra
03.2.4264.00

Digitalni pulsni oksimetar s EKG-om
Šifra
M800Vet
M800Vet digitalni pulsni oksimetar s EKGom, velikim LED zaslonom u boji, visoke rezolucije 320x240 piksela. Mjerenje SPO2 i EKG u isto vrijeme. Zaslon s automatskom rotacijom. Zaštita od ulaska tekućine (IPX2 vodootporan) SPO2 senzor dolazi s dvije kopče za različite veličine životinja. Vizualni i zvučni alarm. Prikladne alkalne ili punjive litijeve baterije veličine AA. 3AA baterije osiguravaju 16 sati neprekidnog rada. Veličina: 58,5x123x28 mm. Zaštitna torbica.


Izuzetno lagan za nošenje i rukovanje, samo 0,5 kg s potpunom konfiguracijom, uključujući bateriju. Zaslon 4,3", rezolucija 480x272 piksela, otporan na dodir, četiri smjera autorotacije. Zaštita od ulaska tekućine (IPX2 vodootporan). Posebno dizajniran filter za vodu, koji osigurava da vlažno okruženje ne utječe na očitanja. Litijska baterija velikog kapaciteta za do 18 sati korištenja. CO2 tipka za pokretanje/isključivanje radi uštede energije. Konfiguracije: EtCO2, Respiration Rate. Veličina: 142x78x36 mm. DODACI KONFIGURACIJA (uključeni u cijenu): SPO2 i Pulse Rate
Uređaj za mjerenje glukoze i mokraćne kiseline u krvi s velikim LCD zaslonom koji automatski identificira testne trakice; raspon mjerenja: glukoza: 20 do 600 mg/dL (1,1 do 33,3 mmol/l), mokraćna kiselina: 3 do 20 mg/ dl (179 do 1190 mmol/l); kapacitet memorije: pohrana 200 rezultata za glukozu i 100 rezultata za mokraćnu kiselinu. Vrijeme mjerenja: 10 s za glukozu i 20 s za mokraćnu kiselinu; uzorak: 4μl. Dodatna oprema: lancetar s 20 lanceta, kodna trakica, dvije baterije, torbica za uređaj, dnevnik mjerenja, jedan utor za trakicu jednostavan za uporabu, 10 trakica za mjerenje glukoze, 10 trakica za mjerenje mokraćne kiseline. KaWe
03.2.4265.00 | Trakice za mjerenje šećera u krvi (glukoza)
03.2.4266.00 | Trakice za mjerenje mokraćne kiseline
Dijagnostička svjetiljka
Šifra
01.9.1942.00

Robusno metalno kućište. Vakuumska žaruljica od 2,5 V. Zoom: 2x, specijalna žarišna duljina. Metalna drška za bateriju/punjenje C. Podešavanje intenziteta svjetla pomoću reostata. Baterije: 2 C baterije (nisu uključene). Mogućnost punjenja baterije u postaji za punjenje KaWe MedCharge 4000.Dodaci: 3 lijevka za višekratnu upotrebu (Ø 4,0 mm / 5,0 mm / 7,0 mm), torbica s patentnim zatvaračem.
Refleksni čekići
01.6.0070.00
01.6.0074.00
01.6.1533.00


Rossmax | Digitalni toplomjeri
Šifra Opis


TG100 čvrsti vrh | mjerenje u 60 sek
TG 380 fleksibilni vrh | mjerenje u 10 sek
Za oralnu, rektalnu i pazušnu uporabu.
Tehničke karakteristike:
• Alarm za vrućicu

• Indikator istrošenost baterije
Dijagnostička svjetiljka napravljena od u bijeloj boji. Gumb za uključenje na vrhu. Uz svjetiljku dolaze tipa ‘AAA’ za napajanje.
• Automatsko isključivanje
• Moguće mjerenje u °C i °F
• Samodijagnoza u slučaju kvara
• 5 godina jamstva
Medico Plus laboratorijska centrifuga
03.3.5763.00
Najpopularniji model sada je dostupan s motorom bez četkica, sigurnosnom blokadom vrata, digitalnim indikatorom brzine i mjeračem vremena.
Tehničke karakteristike:
• S kutnim rotorom (8-cijevi), elektronika kontrolirana mikroprocesorom, VFD kontrola brzine, zeleni LED zaslon.
• Brzina ± 10 RPM, timer 99 minuta
• Najveća brzina: 4000 okretaja/ min; maksimalna RCF (relativna centrifugalna sila): 2270g.
• Dimenzije: 325x370x280 mm.

Šifra
BOE
Binokularna glava, nagnuta za 30°, rotira za 360°. Međuzjenična udaljenost 55 - 75 mm. Par okulara sa širokim vidnim poljem WF 10x/18. 4 BOECO akromatska DIN objektiva: 4x/0.10; 10x/0.25; 40x/0.65, na opruzi; 100x/1.25, s uljem, na opruzi. Pločica za uzorke 140x140 mm. Podržava niže pozicije, koaksijalna kontrola grubog i kalibrirana kontrola finog fokusa. Gradacija: 2 mikrona. Ukupni raspon fokusa 24 mm, s autofokus stopom. Kondenzator Abbe Brightfield, n.A. 1,25. Halogena žarulja 6V 20W, moguće je prilagoditi intenzitet.

Laboratorijska centrifuga Microspin 12
BS-010213-AA1
Koristi se za ekstrakciju RNA/DNA uzoraka, sedimentaciju bioloških komponenti i kemijsku analizu mikrouzoraka.
Tehničke karakteristike:
• Raspon kontrole brzine: 100–14,500 rpm
• Ubrzanje 14,500 rpm (20 sekundi)
• Dimenzije: 200 × 240 × 125 mm
• Masa: 3.5 kg

• Dolazi u setu sa rotorom MSR-12 - rotor sa 12 mjesta za tubice 1.5/2 ml i adapterima: A-02 adapter i A-05 adapter
Sterilizator
40 l ST – 01/02

Manji sterilizator; namijenjen za suhu sterilizaciju instrumenata, sušenje i sterilizaciju laboratorijskog posuđa, te za zagrijavanje raznih materijala na temperaturi do 200°C. Jednostavan za rukovanje s točnošću regulacije ±5°C; automatika termostata omogućava rad bez nadzora. Vrata su jednokrilna i prozirna, bez bravice za zaključavanje. Dimenzije radnog prostora: 440×300×300 mm. Vanjske dimenzije: 575×510×420 mm. Temperaturno područje: 50° - 200° C. Priključni napon: 220 V, 50 Hz. Snaga grijača: 900 W. Masa aparata (bruto/neto): 30/29 kg.
Elektrokirurški uređaj DIATROM 50 W
06.5.1945.00

Monopolarni elektrokirurški uređaj s visokofrekventnim rezanjem i koagulacijom za manje operacije. Načini rada: čisti rez, rez/koagulacija, koagulacija. Širok raspon primjena: dermatološka, kozmetička, dentalna i oralna kirurgija, plastična, estetska, veterinarska kirurgija.
Tehničke karakteristike:
• Snaga: 40-50 W
• Radna frekvencija: 600 kHz
• Dimenzije: 190x239x85 mm
• Težina: 2,5 kg
Elektrokirurški uređaj DIATROM 80 W | 120 W | 160 W
06.5.2624.00
06.5.3134.00
06.5.2334.00

Monopolarni elektrokirurški uređaj s visokofrekventnim rezanjem i koagulacijom za manje operacije. Mogućnost odabira funkcija uređaja: čisti rez (CUT), rez uz koagulaciju (BLEND), površinska koagulacija (COAG FORCED), duboka koagulacija bez karbonizacije (COAG SOFT) te bipolarna koagulacija (BIPOLAR) uz posebni adapter.
Tehničke karakteristike:
• Snaga: 80 - 120 W
• Radna frekvencija: 600 kHz
• Dimenzije: 254x288x104 mm
• Težina: 5-7 kg
Boca za kisik, 2 litre, prazna Boca za kisik, 3 litre, prazna
Šifra
BO.100.15032
Šifra
BO.100.15033

Boca za kisik, 5 litara, prazna
Šifra
BO.100.15035
BO.100.15038
Boca za kisik, 10 litara, prazna

Kolica za bocu za kisik od 3, 5 ili 10l
Šifra
CO.100.18053
5% PDV
Profesionalni prijenosni aspirator na baterije Aspira Go | FLAEM
Opis
TOW000634 Aspira Go 20 - usisni protok od 30 l/min.
TOW000635 Aspira Go 30 - usisni protok od 30 l/min.
TOW004400 Torba za Aspira Go
Kolica u bijeloj boji na kojima stoji i vozi se boca za medicinski kisik. 5% PDV 5% PDV
Proizveden je u skladu sa EN ISO 10079-1 standardom a deklarirani protok ispitan je i potvrđen od strane TÜV Rheinland.
Tehničke karakteristike:
• Napon: 12V
• Dimenzije uređaja: 36(D) x 14(Š) x 27(V) cm
• Težina: 2,5 kg
• Vrijeme korištenja: 30 minutes ON/ 30 minutes OFF
• Aspiracija: Jak vakuum/jak protok
• Podesiva razina vakuuma: Otprilike -0.10 do -0.80 bara (točnost razreda 2,5)
• Max. Protok zraka: Otprilike 20 l/min
• Razina buke (na 1 m): Otprilike 63 dB (A)
• Vrijeme punjenja baterije: 7 sati (minimalno)



Sadrži:
• Posudu od 1000 ml
Profesionalni prijenosni aspirator Aspira Plus | FLAEM

Aspira Plus aspirator u skladu je s normom EN ISO 10079-1. Deklarirani protok od 20 l/min je testiran i potvrđen od strane TÜV Rheinlanda.
Kućište je izrađeno od vrhunske plastike, što osigurava robusnost pri intenzivnoj upotrebi.
Tehničke karakteristike:


• Patentirani sustav ASPICOMFORT za preciznu kontrolu razine aspiracije
• Patentirani držač za posude: fleksibilan, stabilan, jednostavan za čišćenje
• Boca od 1 litre (1 uključena) - autoklavabilna
• Protok od 20 l/min
• Podesiva razina vakuuma
• Tih rad - 56dB
• Posuda i cijevi se mogu sterilizirati
• Cijevi izrađene od silikona
• Antibakterijski filter
• Napajanje 220V / 50 Hz
• Dimenzije uređaja: 325 x 120 x 235 mm / težina 2,4 kg
FLAEM | Rezervni komplet za Aspira Go 20 FLAEM | Držač za posudu FLAEM | Antibakterijski i antivirusni filter, 2 kom FLAEM | Brtva kompresora za Aspira Go
• Filter
• Crijevo


Idealan za njegu pacijenata poslije traheotomije, manje operativne zahtjeve te za postoperativnu bolničku i kućnu njegu.
Tehničke karakteristike:
• Visok vakuum / niski protok

• Maksimalni vakuum (na ulazu pumpe): -73 kPa/ -550 mmHg
• Maksimalni usisni protok (na ulazu pumpe): 16 l/min
• Adapter, ulaz: AC 100-240V, 50/60Hz
• Adapter, izlaz: DC 12V 2.0A
• Zapremnina sabirnog spremnika: 1.4L (Polikarbonat, PC)
• Potrošnja struje: ≤ 24W
Pumpa visokih performansi pruža vakuum od -600 mmHg i protok od 30 litara/min.
Zaštitni ventil protiv prelijevanja plus antibakterijski filter i intuitivan dizajn uređaja spriječavaju vraćanje tekućine i ulazak vanjskih onečišćivača u pumpu. Držač cijevi, posuda za odlaganje cijevi i pretinac za pribor omogućuju jednostavno spremanje. Sveobuhvatna nadzorna ploča s ergonomskim kutem gledanja osigurava nesmetan rad. Jednostavno otvaranje poklopca na gumb.


Idealan za njegu pacijenata poslije traheotomije, manje operativne zahtjeve te za postoperativnu bolničku i kućnu njegu.
Tehničke karakteristike:
• Visok vakuum / visoki protok
• Maksimalni vakuum (na ulazu pumpe): -80 kPa/ -600 mmHg
• Maksimalni usisni protok (na ulazu pumpe): 30 l/min
• Napajanje: AC 100-120V, 50/60Hz ili AC220-240V, 50/60Hz
• Zapremnina sabirnog spremnika: 1.4L (Polikarbonat, PC)
• Potrošnja struje: ≤ 55W
Šifra Opis
SU_AC_003_00 za aspirator V3
Antibakterijski filter komplet za aspirator V3, V5 i V7
SU_AC_002_00 za aspirator V5/V7 Šifra
SU_AC_004_00
Samošireći balon za reanimaciju, PVC Šifra
07.2.1362.01
07.2.2909.02
07.2.2909.03
Za jednokratnu upotrebu.



Samošireći balon za reanimaciju, silikonski
Šifra
07.2.1362.01
Može se sterilizirati u autoklavu.

Drška za metalnu lopaticu laringoskopa »Italy« Ø 28 mm standardna (C)

Metalne lopatice “Italy” (C)



Cijev za aspiratore V3, V5 i V7
SU_AC_001_00

Endotrahealni tubusi, sterilni, za jednokratnu upotrebu
TRAH-TUB-CH-10 | vel. 2, 10 CH

TRAH-TUB-CH-12 | vel. 2,5, 12 CH
TRAH-TUB-CH-14 | vel. 3, 14 CH
TRAH-TUB-CH-16 | vel. 3,5, 16 CH
TRAH-TUB-CH-18 | vel. 4, 18 CH
TRAH-TUB-CH-20 | vel. 4,5, 20 CH
TRAH-TUB-CH-22 | vel. 5, 22 CH
TRAH-TUB-CH-24 | vel. 5,5, 24 CH
TRAH-TUB-CH-26 | vel. 6, 26 CH
TRAH-TUB-CH-28 | vel. 6,5, 28 CH
TRAH-TUB-CH-30 | vel. 7, 30 CH
TRAH-TUB-CH-32 | vel. 7,5, 32 CH
TRAH-TUB-CH-34 | vel. 8, 34 CH
TRAH-TUB-CH-36 | vel. 8,5, 36 CH
TRAH-TUB-CH-38 | vel. 9, 38 CH
TRAH-TUB-CH-40 | vel. 9,5, 40 CH
TRAH-TUB-CH-42 | vel. 10, 42 CH
Kirurške škare se koriste prvenstveno za rezanje tkiva, šavova te medicinskih potrošnih materijala poput zavoja i kompresa. Načinjene su od vrhunskog nehrđajućeg čelika, a dolaze u nekoliko različitih duljina, te u ravnim i zakrivljenim varijantama sa svim konfiguracijama vršaka (Tupo-tupe; Šiljato - tupe; Šiljato - šiljate)
Rebstock | Standardne | RAVNE




Rebstock | Standardne | ZAKRIVLJENE




Standardne | RAVNE Standardne | ZAKRIVLJENE
vađenje konca
Koriste se za uklanjanje konaca. Škare imaju mali kukasti vrh na jednoj od oštrica pomoću kojeg se konac može lagano podići prije presijecanja odnosno uklanjanja. Kukica također drži konac tako da ne sklizne s oštrice škarica prije presijecanja. Dostupne u dvije varijante po dužini. Izrađene od nehrđajućeg čelika.


Po Metzenbaumu | Tupo-tupe

Metzenbaum škare dostupne su u dvije varijante po obliku - zakrivljene i ravne, te u nekoliko različitih dužina. Namijenjene su za rezanjeosjetljivog i delikatnog tkiva. Same škare imaju veoma duge drške u odnosu na oštrice. Ovaj tip škarice je najčešće korišten u većini operacija organa te u operativnih zahvatima srca.

Duljina (cm) Šifra 12 08.280.12
08.280.15 18 08.280.18 20 08.280.20 23 08.280.23 25 08.280.25



(cm) Šifra 18 05.1.1812.00


Škare za zavoje po Listeru se obično koriste pri rezanju i oblikovanju zavoja te otklanjanju kompresa. Također se koriste i za rezanje čvrstih materijala poput gipsa, tkanine a ponekad i pupčane vrpce. Oštrice škara su nakošene s time da je donja oštrica malo dulja od gornje. Vršak donje oštrice je plosnat i tup kako bi se lakše mogao uvući između zavoja i kože bez rizika da ju poreže. Ponekad se koriste pri carskom rezu kod otvaranja maternice kako bi se izbjeglo ozljeđivanje djeteta. Dostupne u četiri veličine, izrađene od nehrđajućeg čelika.




Hemostatska hvatalica po Rochester-Peanu se koristi za stezanje većih žila i tkiva radi hemostaze. Rezovi duljinom cijelog vrha te dostupnost u različitim duljinama čine ovu hvataljku višenamjenski korisnim instrumentom korištenim u velikom broju zahvata. Dostupne u ravnoj i zakrivljenoj varijanti. Izrađene od nehrđajućeg čelika.



Hvatalice po KOCHERU



Hvatalica za arterije po Kocheru s unutarnje strane ima zubac, a na suprotnoj strani ležište. Namijenjena je za agresivno hvatanje srednje do teškog tkiva ili zatvaranje teških i gustih krvnih žila. Oba kraka su unutarnjom dužinom izbrazdana dok se na vrhu nalazi zubac što omogućava čvrsto držanje tkiva ili arterije.


Hvatalica po Mosquitu





Hvatalice po Mosquitu su hemostati s okruglim prstenastim drškama te nazubljenim vršcima. Koriste se za razne kirurške zahvate, primjerice za zaustavljanje krvarenja kod površinskih ozljeda.


Hvatalica za vađenje stranih tijela
Hvatalica koja se prvenstveno koristi za uklanjanje stranih tijela iz nosa i ušiju. Izrađena od nehrđajućeg čelika.
Duljina (cm) Šifra
16,5 05.1.0361.00


Iglodržači po Mayo Hegaru
Iglodržač po Mayo Hegaru je podesivi instrument s okruglim drškama koji se koristi za niz kirurških procedura. Izrađen od nehrđajućeg čelika.
Duljina (cm) Šifra

Anatomska pinceta ima tupe i zaobljene krakove. Služi za hvatanje krvnih žila i živaca. Izrađene od nehrđajućeg čelika.

Šifra Vel (cm)
10.102.11 11,5
10.102.13 13
10.102.14 14,5
10.102.16 16
10.102.18 18
10.102.20 20
10.102.23 23
10.102.25 25 10.102.30 30
Šifra Vel (cm)
05.1.0193.00 14
05.1.0194.00 16
05.1.0942.00 18
05.1.0505.00 20
05.1.0675.00 25 05.1.1074.00 30


Kirurška pinceta sa zupcima za držanje i hvatanje tkiva. Izrađene od nehrđajućeg čelika.

Šifra Vel (cm) 10.120.11 11,5
13
14
16
20
30

Šifra Vel (cm)
05.1.0203.00 14
05.1.0204.00 16
05.1.0522.00 18 05.1.0664.00 20 05.1.1768.00 25

Skalpel (plastična drška + nožić) sterilni
Jednokratni skalpeli s drškom. Namijenjeni za jednokratnu upotrebu. Pakovanje sadrži 10 komada.
fig. Šifra
10 05.1.4785.01
11 05.1.4785.02
12 05.1.4785.03
15 05.1.4785.04
18 05.1.4785.05
20 05.1.4785.06
21 05.1.4785.07
22 05.1.4785.08
23 05.1.4785.09
24 05.1.4785.10

Skalpel-nožić od nehrđajućeg čelika
Šifra
05.1.0200.01

Pincete po ADSONU
Služi za hvatanje krvnih žila i živaca, vađenje stranih tijela i male kirurške zahvate. Izrađene od nehrđajućeg čelika.


Otvarač usta za glodavce
Namijenjen veterinarima.

Jednokratne sterilne skalpel oštrice
Sterilizirane su gama zračenjem i zapakirane u aluminijske sterilne spremnike. Oštrice se razlikuju po obliku i namjeni, a prvenstveno se koriste za rezanje tkiva i šavova. Pakovanje sadrži 100 oštrica.
fig. Šifra
10
05.1.1321.01
11 05.1.1321.02 12 05.1.1321.03 15 05.1.1321.04
20 05.1.1321.05
21 05.1.1321.06
22 05.1.1321.07
23 05.1.1321.08
24 05.1.1321.09
Drška za skalpel

Šifra
05.1.0201.00
05.1.0403.00

Bubnjevi za sterilizaciju | Titanox
Bubnjevi za sterilizaciju izrađeni od visokokvalitetnog nehrđajućeg čelika. Pogodni za sterilizaciju u autoklavu i suhom sterilizatoru.
Dimenzije (mm) Šifra
125 x 80 A1-001-125
125 x 100 A1-002-125
125 x 125 A1-003-125
150 x 80 A1-004-150
150 x 100 A1-005-150
150 x 130 A1-006-150
150 x 150 A1-007-150
150 x 190 A1-008-150
190 x 125 A1-009-190
190 x 145 A1-010-190
190 x 165 A1-011-190
190 x 190 A1-012-190
190 x 240 A1-013-190
240 x 165 A1-017-240
240 x 240 A1-019-240
290 x 165 A1-024-290
290 x 190 A1-025-290
290 x 290 A1-027-290
340 x 165 A1-031-340
390 x 240 A1-040-390
Igle za biopsiju
Igle za biopsiju
Promjer Šifra
1 mm GIM-22610
1,5 mm GIM-22611
2 mm GIM-22612
2,5 mm GIM-22613
3 mm GIM-22614
3,5 mm GIM-22615
4 mm GIM-22616
5 mm GIM-22617
6 mm GIM-22618
8 mm GIM-22619



za sterilizaciju | Titanox
Kutije za sterilizaciju izrađene od visokokvalitetnog nehrđajućeg čelika.
Dimenzije (mm) Šifra
180 × 80 × 40
A2-168-180
200 × 100 × 50 A2-169-200
220 x 120 x 60 A2-170-220
250 x 120 x 60 A2-171-250
300 x 120 x 60 A2-172-300
320 x 150 x 60 A2-173-320
400 × 160 × 70 A2-174-400


Bubrežaste zdjelice izrađene od visokokvalitetnog nehrđajućeg čelika.
Duljina (mm) Zapremnina Šifra
200 300 cc A5-281-020
250 600 cc A5-282-025
280 1000 cc A5-283-028
Jednokratna sterilna klamerica
Šifra
GIM-25891

Dužina oštrice 7 mm Oštar rezni rub od nehrđajućeg čelika, rebrasta ručka za siguran hvat. Veličina utisnuta na svakoj igli za lakšu identifikaciju. Svaki udarac je zasebno zapečaćen u prozirnom pakiranju koje se odvaja.


Jednostavna i lagana za rukovanje. Izrađena od visokokvalitetnog nehrđajućeg čelika 317 L za medicinsku upotrebu. Smanjena reakcija tkiva, tanji ožiljak nakon operacije i brže zacjeljivanje rana. Bezbolno i praktično uklanjanje spajalica nakon što je rez zacijelio. Koristi se za zatvaranje kože u operacijskoj sali, porođaju, hitnoj pomoći, ambulantnoj kirurgiji, klinikama i liječničkoj ordinaciji.
Šifra GIM-24100

Za ispitivanje glukoze, askorbinske kiseline, ketona, proteina, pH-vrijednosti, krvi, nitrita, leukocita, specifične težine, bilirubina, urobilinogena.
Šifra GIM-80301
Veterinarski operacijski stol s električnim podizačem (82/102 cm), cijevnim okvirom od pečenog emajliranog čelika i pločom od nehrđajućeg čelika AIsI 304 (120x56 cm) s rupom i držačem kante za tekućinu ispod. Bočna kuka za imobilizaciju životinja. Proizvedeno u Italiji.
Tehničke karakteristike:
• Veličina: 118x56x85/102 cm
• Težina: 50 kg

• Maksimalno opterećenje: 90 kg
Šifra GIM-80300
Veterinarski operacijski stol s emajliranim cijevnim čeličnim okvirom, s gornjom površinom od nehrđajućeg čelika AISI 304 15/10 s rupom i držačem posude za tekućinu ispod. Bočna kuka za imobilizaciju životinja. Proizvedeno u Italiji.

Tehničke karakteristike:
• • Veličina: 120x58x85 cm
• Težina: 24 kg
• Maksimalno opterećenje: 60 kg
Modularna digitalna vaga s dužinomjerom Vitammy GROW
Šifra
TOW016686
Tehničke karakteristike:
• Napajanje: 2 x AAA, 1,5 V baterije

• Načini rada: mjerenje težine, mjerenje dužine (do 60 cm), tare funkcija, funkcija Hold, automatsko isključivanje
• Nosivost: 100 kg
• Zaslon: LED, 55 x 22 mm
• Indikatori: indikator preopterećenja, indikator slabe baterije
• Odabir jedinica mjerenja: kg/lb/oz
Šifra MM6470

Dječja vaga sa plastičnom posudom koja se koristi i za bebe. Posuda za bebe se može maknuti pa se koristi i kao dječja vaga.
Tehničke karakteristike:
• Preciznost 10 g i kapacitet 20 kg.
• Funkcija razlike u težini: roditelji mogu pratiti težinu beba nakon hranjenja.
• LCD zaslon, funkcija zaključavanja težine, automatsko isključivanje.
• Tare i autohold funkcija.
• Radi na 2xCR2032 baterije (uključene).
Digitalna veterinarska vaga
Maksimalna masa mjerenja: 100 kg; preciznost: 100 grama. Drveno postolje: 620x830mm. Dizajn prilagođen ljubimcima. Jednostavno za održavanje i čišćenje. LCD zaslon Automatsko gašenje nakon 60 sekundi. Indikator slabe baterije i prekomjernog opterećenja. Mjerne jedinice: kg/ lb/st. Napajanje:CR2032 litijska baterija (uključena).

Nitrilne rukavice s teksturom dijamanta | 50 kom
VELO STRONG nitrilne rukavice s teksturom dijamanta u narančastoj boji. Rukavice pružaju zaštitu od kemikalija u skladu s EN ISO 374-1 te od mikroorganizama u skladu s EN ISO 374-5.
Šifra Veličina
VELO-5049102 S
VELO-5049103 M
VELO-5049104 L
VELO-5049105 XL
VELO-5049106 XXL

Nitrilne rukavice | bez pudera COATS premaz od koloidne zobi | SVIJETLO PLAVE | 200 kom
Šifra Veličina
BEC-50405002 S
BEC-50405003 M
BEC-50405004 L
BEC-50405005 XL



Nitrilne dijagnostičke rukavice s unutarnjim zaštitno-hidratantnim slojem koji sadrži prirodnu koloidnu zob kao sredstvo za zaštitu kože. COATS® je akronim za **Colloidal Oatmeal System** – patentiranu tehnologiju premaza za rukavice koja sadrži klinički dokazanu koloidnu zob za zaštitu kože. CERTIFICIRANE BEZ GLUTENA, sigurne za osobe s celijakijom ili osjetljivošću na gluten. Koloidna zob navedena je kao uobičajeni naziv sastojka za upotrebu u označavanju kozmetičkih proizvoda prema Odluci Komisije (EU) 2019/701 od 5. travnja 2019. godine.
Izvanredna sposobnost prihvata i držanja zahvaljujući posebnoj teksturi. Izrađene od materijala koji osigurava trajnost i fleksibilnost. Omogućava cirkulaciju zraka, što minimizira znojenje ruku.
Šifra Veličina
VELO-5049002 S
VELO-5049003 M
VELO-5049004 L
VELO-5049005 XL
VELO-5049006 XXL

Nitrilne rukavice | bez pudera | crne | 100 kom
Šifra Veličina
VELO-5046202 S
VELO-5046203 M
VELO-5046204 L
VELO-5046205 XL

Pregledne jednokratne zaštitne rukavice izrađene od nitril-butadien gume (NBR), bez pudera, nesterilne imaju slična svojstva i karakteristike koje odgovaraju rukavicama od prirodnog lateksa. U skladu s regulativom za medicinske uređaje 2017/745, EN 455, regulativom za osobnu zaštitnu opremu 2016/425, EN ISO 21420, EN (ISO) 374, EN 16523-1. Univerzalnog su oblika tako da odlično pristaju na lijevu i desnu ruku. Napravljene su bez prirodnog lateksa.
Nitrilne rukavice | bez pudera | ružičaste | 100 kom
Šifra Veličina TOW020945 XS TOW020946 S TOW020947 M


Namjenjeno korištenju u liječničkim ordinacijama, stomatološkim ordinacijama, kozmetičkim salonima, frizerskim salonima i dr. Pruža zaštitu od kemikalija kao zaštitna rukavica tipa B u skladu s EN ISO 374-1. Ispitano na prodor mikroba u skladu s EN 374-5. Rukavice imaju teksturirane vrhove prstiju čime omogućavaju čvrsto prianjanje kod hvata pri radu. Ove rukavice odgovaraju i desnoj i lijevoj ruci.
Nitrilne rukavice | bez pudera | PLAVE | 100 kom
Šifra Vel
SEM-3000012742 XS
SEM-3000012743 S
SEM-3000012744 M
SEM-3000012745 L
SEM-3000012746 XL


Mekani materijal koji je razvijen u Semperit europskom istraživačkom centru omogućava maksimalan osjećaj dodira i udobnost zahvaljujući optimiziranoj debljini stijenke, a istovremeno pruža maksimalnu zaštitu od infekcija. Štiti korisnike i pacijente od prijenosa infekcija prema EN 455-1. Osim zahtjeva za nepropusnost europskog standarda, rukavice također ispunjavaju zahtjeve za nepropusnost virusa prema ASTM F 1671. Materijal rukavice otporan je na krv i druge tjelesne tekućine te štiti od bakterija, gljivica i virusa, uključujući SARS-CoV-2, hepatitis B i C te HIV.
LATEX rukavice | s puderom | BIJELE | 100 kom
Šifra Veličina
1000-LP S
1000-LM M
1000-LG L
24-1020 XL


Zaštitne rukavice od lateksa za jednokratnu upotrebu, s puderom. Specifična izrada za jednostavno rukovanje i spriječavanje pomicanja. Teksturirano za poboljšano prianjanje. Niska razina ekstaktabilnih proteina i kemijskih ostataka. Prikladno za korištenje tijekom rukovanja hranom (food safe). Rukavice imaju sloj prekrivnog pudera. Hipoalergene i ambidekstrozne. U skladu s EN 455. Proizvedeno u skladu s međunarodnim standardom kvalitete ISO 9001, ISO 13485.
Maska za lice troslojna TIP IIR | kirurška | 50 komada | plava
Šifra MASKA SYNEK

Medicinska kirurška zaštitna maska za lice TIP IIR za jednokratnu upotrebu, namijenjena je ograničavanju prijenosa zaraznih agensa s osoblja na pacijente tijekom kirurških zahvata i drugih medicinskih aktivnosti sa sličnim zahtjevima. Također je namijenjena pacijentima i općoj populaciji.
LATEX rukavice | bez pudera | BIJELE | 100 kom
Šifra Veličina
VELO-5040601S XS
VELO-5040602S S
VELO-5040603S M
VELO-5040604S L
VELO-5040605S XL


Velo lateks pregledne rukavice bez pudera namijenjene su jednokratnoj uporabi, rukavice su nesterilne. Dizajnirane su za širok raspon primjena, kao što je na primjer dijagnostika ili za osobne potrebe kao dio zaštitne opreme, za rad s hranom. Vanjska površina rukavice je glatka, bez mjehurića i zadebljanja, mikroteksturirani vrhovi prstiju osiguravaju dobar stisak. Razred I sukladno Direktivi o medicinskim proizvodima 93/42/EEC. Kategorija III sukladno Direktivi o osobnoj zaštiti 89/686/EEC. Usklađenost sa standardima: EN 455-1,2,3,4; EN 374-1, 2, 4, 5; EN ISO 3745; EN 16523-1; EN 388, EN 420:2003+A1:2009; ASTM F 1671. Proizvod je u skladu s uredbom 1935/2004 i odobren je za kontakt s hranom.
12.0.5955.01

OKVIR: 100% polikarbonat (FT). STEM: polikarbonat s fleksibilnim završecima Ecolive®. LEĆA: može se koristiti u ekstremnim temperaturnim uvjetima. DEBLJINA MATERIJALA: Polikarbonat debljine 2,2 mm. BOČNA ZAŠTITA: široka, učvršćena na okvir. TEŽINA: 45 g. MOGUĆNOSTI: Može se nositi i preko korektivnih (dioptrijskih) naočala! LEĆE: Bistra leća (2-1,2 1FT, klasa filtra svjetlosti: 0). EU standard: CE EN166:2001.
Maska za lice FFP2
Šifra Opis
BR150-20N/10 10 kom
BR150-20/50 50 kom

Maska je napravljena od višeslojne netkane tkanine za filtriranje po EN 149:2001 + A1:2009 standardima, CE 0068. Ova trodimenzionalna maska je zbog svoje konstrukcije izuzetno ugodna za nošenje i disanje. Na području nosa učvršćuje se pomoću lako savitljive metalne trakice.

Šifra Opis
12.0.0469.01 plava
12.0.0469.02 crvena


Poveska se stavlja iznad mjesta na kojem će se vaditi krv kako bi vena postala vidljivija a time postupak vađenja krvi lakši i ugodniji za pacijenta.
Šifra 3M-SR3

Vade kopče u istom smjeru u kojem su umetnute, olakšavajući tako vađenje. Jednokratne, ekonomične. Jednostavna upotreba i lako otklanjanje kopči.
Veliki izbor laboratorijskih i potrošnih proizvoda pogledajte u kategoriji 10 i 11
Sterilne posudice za uzimanje uzoraka urina i stolice
Petrijeve zdjelice
Štapići za briseve
Pipete

Jednokratne epruvete
Konusne epruvete za centrifugu
Jednokratne igle za vacutainer epruvete
Šprice, kanile i igle












Jednokratni plastični spremnici otporni na ubode i porezotine za odlaganje igala i infektivnog otpada. Sprječavaju curenje opasnog otpada iz spremnika, te su veoma izdržljivi na udarce. Svi imaju privremene i trajne poklopce, široke otvore za odlaganje te ureze za skidanje igala.
Šifra
LINE -5L 5l
LINE -6I 6l


Šifra
DISPO LINE-0,5I 0,5l
DISPO LINE-0,7I 0,7l
DISPO LINE-1I 1l
DISPO LINE-1,5 I 1,5l
DISPO LINE-2I 2l
DISPO LINE-2,5I 2,5l Šifra
LINE -7I 7l
LINE -12I 12l


















Pregledni ležajevi ....................................................................... 176-179
Potrošni materijal za pregledne ležajeve 179
Kolica za prijevoz pacijenta | strecheri ........................... 180-181
Operacijski stolovi 182-184
Bolnički kreveti 185-187
Madraci za bolničke krevete ......................................................... 187
Rješenja i sustavi poziva medicinskih sestara 188-189
Dodaci za bolničkie krevete 190 Stalci za infuziju ..................................................................................... 191
Dvodjelni pregledni ležaj | D-16-1
Šifra Boja
D-16-1-2001 bijela
D-16-1-2000 crna
Dvodjelni pregledni ležaj napravljen je od nehrđajućeg čelika. Noge stola: moguće ih je ukloniti. Sastoji se iz 2 dijela, oba obložena visokokvalitetnom umjetnom kožom. Sustav za vješanje medicinske role: može se postaviti na strani glave ili nogu. Ležaj dolazi s nogama koje je moguće ukloniti. Dimenzije: 185x65 x65 cm.


Dvodjelni pregledni ležaj s otvorom za glavu i lice na uzglavlju | D-19-1
Šifra Boja
D-19-1-2001 bijela
D-19-1-2000 crna
Dvodjelni pregledni ležaj izrađen je od kvalitetnog nehrđajućeg čelika (Inox AISI 304). Ležeća površina presvučena je umjetnom kožom visoke kvalitete. Opremljen je uzglavljem s automatski po visini podesivim nagibom te sustavom za vješanje medicinskih rola na uzglavlju ili podnožju ležaja. Na uzglavlju se nalazi otvor za glavu i lice. Ležaj ima mogućnost pomicanja nogu. Dimenzije: 185x65x70 cm.


Trodijelni pregledni ležaj
Šifra
M600320/B
Trodjelni pregledni ležaj čiji okvir je izrađen od nehrđajućeg čelika. Dimenzije: 180x60 cm. Visina 78 cm. Periva presvlaka. Držač za papir nije uključen u cijenu.

Dvodjelni pregledni ležaj | D-18-1
Šifra Boja
D-18-1-2001 bijela
D-18-1-2000 crna
Dvodjelni pregledni leža izrađen je od kvalitetnog nehrđajućeg čelika. Ležeća površina presvučena je umjetnom kožom visoke kvalitete. Opremljen je i zaobljenim uzglavljem s automatski po visini podesivim nagibom te sustavom za vješanje medicinskih rola na uzglavlju ili podnožju ležaja. Ležaj dolazi s nogama koje je moguće ukloniti. Dimenzije: 185x65x70 cm.


Pregledni ležaj | TITANOX
Šifra Boja M600357 bijela
M600357/C crna T1000 plava
Okvir kreveta je izrađen od čelične ovalne cijevi s epoksi premazom. Podesiv naslon za leđa. Postava je izrađena od guste poliuretanske pjene, nezapaljiva, klasa 1 IM. Tapecirano je perivim, nezapaljivim plastičnim materijalom klase 1 IM. Prilagodljive gumene nožice. Stol dolazi s držačem papirne role smještenim na stražnji dio preglednog ležaja. Nosivost: 150 kg. Dimenzije: 192x60 cm, visina 78 cm.


Drveni pregledni ležaj
Šifra
15.1.0845.00
Drveni stol za preglede. Otporna pjenasta podloga s perivom presvlakom od umjetne kože. Dimenzije: 194×70×55 cm.


Pregledni ležaj | ECOPOSTURAL | C4520 (model M44)
Šifra
ECO-C4520
Pregledni ležaj s podesivom visinom uzglavlja visine je 75 cm. Gornji dio stola podiže se ručno do kuta od 65°. Stol ima uklonjive noge. Ležaj od poliuretanske pjene debljine 5 cm s ocjenom mekoće II (mekan) omogućuje udobnost tijekom pregleda/tretmana. Opremljen držačem za rolu papira, ovaj stol pojednostavljuje svakodnevni rad. Vrlo je čvrst, podnosi težinu do 135 kg. Proizveden u Španjolskoj, ovaj stol zadovoljava sve CE standarde. Visina: 75 cm. Dužina: 188 cm (pomično uzglavlje po visini dužine je 75 cm, fiksni dio ležaja je 112 cm dužine). Širina: 62 cm. Pomično uzglavlje: ručno se podiže do kuta od 65°.
Pregledni ležaj | KAWE
Šifra Boja
15.1.3739.01 crna
15.1.3739.02 plava
15.1.3739.03 siva
Njemačka kvaliteta, izvanredan i moderan dizajn. Višenamjenski stol s okvirom od čelika lakiranog bojom u prahu. Nagib podesiv do 50 stupnjeva u 10 koraka. Periva presvlaka odumjetne kože. Držač role papira. Dimenzije: 195×65×65 cm. Nosivost: 180 kg.

Pregledni stol za PEDIJATRIJU | ECOPOSTURAL | C4548 (model M40)
Šifra
ECO-C4548

Sastoji se od dva dijela i posebno je dizajniran za rad s djecom. Opremljen je uklonjivim nogama za lakše prilagođavanje prostoru. Ležaj od poliuretanske pjene debljine 5 cm s ocjenom mekoće II (mekan). Ležaj je prekriven presvlakom od umjetne kože otporne na vatru (klasa M2). Čelični okvir stola zaštićen je s bijelim epoksi premazom. Visina: 75 cm. Dužina: 140 cm (pomično uzglavlje po visini dužine je 45 cm, fiksni dio ležaja je 93 cm dužine). Širina: 62 cm. Pomično uzglavlje: ručno se podiže do kuta od 40°. Maksimalna nosivost: 135 kg. Stol zadovoljava sve CE standarde
ležaj | REXMÖBEL


Šifra
15.1.0865.01
Okvir od cjevastog čelika lakiranog bojom u prahu, uzglavlje podesivo po želji. Tapeciran pjenastom podlogom debljine 5 cm s perivom presvlakom od umjetne kože bez šavova, u boji po izboru. Osnovna boja: bijela. Čvrsta konstrukcija. Jednostavno održavanje. Dostupne boje: bijela, narančasta, crna, bordo i bež. Dimenzije: 190×80×50 cm. Nosivost: 250 kg.

Pregledni ležaj za djecu
15.1.5487.00

Uzglavlje podesivo po želji. Dvodijelna periva podstava. Dimenzije: 65×60×80 cm. Čvrsta konstrukcija. Stol se isporučuje rastavljen.
Šifra Boja | opis
15.1.4354.01 bijela | fiksna visina
15.1.4355.01 bijela | podesiva visina
Dvodijelni višenamjenski stol s okvirom od cjevastog čelika lakiranog bojom u prahu. Podesivo uzglavlje: od 0° do 45°. Tapeciran pjenastom podlogom debljine 5 cm s perivom presvlakom od umjetne kože bez šavova, u boji po izboru. Jednostavno održavanje. Osnovna boja: bijela. Čvrsta konstrukcija. Dostupne boje: bijela, narančasta, crna, bordo i bež.


Tehničke karakteristike:
• Dimenzije: 190×60×75 cm
• Nosivost: 250 kg
Tehničke karakteristike:
• Podesiva visina: od 50 do 85 cm
• Dimenzije: 190×60×75 cm
• Nosivost: 150 kg

Uzglavlje podesivo po želji. Dimenzije: 190×60×75 cm. Opcija: držač role papira. Stol za preglede s obojenim okvirom i dvodijelnom, perivom, podstavom od umjetne kože. Dostupne boje: bijela, narančasta, crna, bordo i bež.
Ecopostural C6880 Hidraulički stol s dva segmenta – za trudnice i osobe s izraženim trbuhom
Šifra ECO-C6880
Posebno je dizajniran za pacijente s izraženim trbuhom, poput trudnica, osoba s respiratornim poteškoćama, pretilim osobama i sl. Ovaj stol nudi izuzetan komfor prilikom ležanja na trbuhu zahvaljujući središnjem pneumatskom modulu.
Tehničke karakteristike:
• Tip: Dva segmenta
• Podešavanje visine: Od 53 cm do 93 cm, uz nožne pedale

Hidraulički sustav, podizanje do 65°
• Debljina pjene: 5 cm, tip II –uravnotežena podrška
• Dimenzije: Širina 62 cm ili 70 cm, duljina 200 cm
• Dužina naslona: 65 cm
• Dužina ležaja (bez naslona): 135 cm
• Podešavanje nagiba naslona:
• Maksimalno opterećenje: Preporučeno do 175 kg (testirano do 250 kg)
• Proizvođač: Ecopostural (Španjolska)
• Standardi: CE
Električni profesionalni pregledni ležaj
Šifra DP S808
Električno podesivi stol omogućuje podizanje cijele površine na visinu između 50 i 90 cm. Visina stola se podešava elektromotorom s ručnim prekidačem, naslon za leđa ima dvije zračne opruge do 85° i -30° za lakše podešavanje položaja. Veliki ovalni otvor na licu - dužina 19 cm, širina 9 cm! Vrlo je stabilan zbog svog kompaktnog okvira. Širina: 70 cm, duljina: 200 cm, podešavanje visine: 40-90 cm, dinamičko opterećenje: 350 kg, statičko opterećenje: 160kg, dužina podiznog dijela: 58 cm, težina: 73 kg.

Šifra Opis
MI395B hidraulični
MI390B električni
Cjevasti čelični okvir u boji. Otvor za glavu na uzglavlju, poliuretanska podstava gustoće 25 i visine 8 cm. Periva i nezapaljiva presvlaka od skaja, klasa 1IM.
MI395B | hidraulični
Dimenzije: 203,5 x 92 x 52-86 cm (v)
Težina: 75 kg. Kapacitet: 180 kg.
MI390B | električni
Dimenzije: 202 x 92 x 52-92 cm (v)
Težina: 75 kg. Kapacitet: 200 kg.


Pregledni stol podesive visine
Šifra Boja
15.1.1628.01 bijela
15.1.1628.02 bež
15.1.1628.03 plava
Trodijelni stol za preglede s otvorom za lice i uzglavljem koje se može skinuti. Tri ergonomski oblikovana dijela pružaju više fleksibilnosti: mogućnost konfiguracije stola ili stolca. Visina podesiva pomoću elektromotora. Dva pokretljiva dijela, nožni dio i uzglavlje, mogu se podesiti pomoću plinske pumpe. Vatrootporna podstava debljine 75 mm. Fiksni prednji kotačići, mogućnost uvlačenja stražnjih kotačića. Maksimalna težina pacijenta: 150 kg. Dužina: 70 cm (noge) x 57 cm (sredina) 57,5 cm (uzglavlje). Visina: 45-98 cm. Širina: 60 cm.

Električni profesionalni pregledni ležaj
Šifra LUX-12348864
Električni jednodjelni pregledni sto veličine 190x100cm ili 200x120cm s podesivom visinom. Španjolski proizvod s oznakom CE. Maksimalno podizanje do 180 kg. Električno podesiva visina od 50 do 85 cm. Podesivo postolje za stabilnost na neravnim površinama. Presvlake: E30 / 5 - pjena 30Kg / m3 5cm presvučena visokokvalitetnom medicinskom kožom. Težina: 150 kg. Konstrukcija je premazana prahom na 210ºC.


Pregledni stol, električno podesive visine
Šifra Boja
15.1.5358.01 bijela
15.1.5358.02 narančasta
15.1.5358.03 crna
15.1.5358.04 bordo
15.1.5358.05 bež

Jednostavan za čišćenje, presvlake visoke kvalitete, termički ljepljene. Posebno oblikovana spužva. Elektrostatički plastificiran i s kromiranim dijelovima, plastične obloge visoke čvrstoće koje je moguće sterilizirati. Napajanje: 230 / 24V, 20 VA transformatora s dvostrukom izolacijom. Veličina ležaja: 190 × 70 cm. Visina 60-90 cm električno podesiva pomoću pedale. Težina stola: 80 kg, nosivost: 150 kg. Primarna boja: bijela, druge boje su dostupne uz nadoplatu (vidi tablicu).
Električni ginekološko urološki ležaj
Visina podesiva pomoću elektromotora, od 62 do 92 cm. Mehanički podesiv nagib naslona za leđa – od 0 do 70°, nagib naslona za noge – od 0 do 90°.
Okvir lakiran bojom u prahu. Podnožje moguće nivelirati. Odvojivi nasloni za ruke. Tapeciran pjenastom podlogom debljine 5 cm s perivom presvlakom od umjetne kože bez šavova. Dimenzije: 65×180 cm; Težina: 70 kg. Maksimalna težina pacijenta: 150 kg. Dostupne boje: bijela, narančasta, crna, bordo, bež, svijetlo zelena i žuta.


Okvir od čelika lakiranog bojom u prahu. Tapeciran pjenastom podlogom s perivom presvlakom od umjetne kože bez šavova. Mehanički podesiv naslon za leđa i noge, mogućnost postavljanja u vodoravni položaj. Odvojivi nasloni za ruke. Hidraulički podesiva visina, od 52 do 67 cm. Dizanje, spuštanje i rotacija od 360° pomoću poluge. Dimenzije: 60 cm širina (83 cm s naslonima za ruke); dubina sjedala 45 cm; težina: 50 kg. Maks. dužina u horizont. položaju 160 cm. Maksimalna težina pacijenta: 150 kg. Dostupne boje: bijela, narančasta, crna, bordo i bež.
Električni ginekološko urološki ležaj | LAK 1705
Električni ginekološki stol s 2 motora za podešavanje visine i postavku leđnog nagiba. Maximalna težina do 180 kg. Električno podesiva visina od 53 do 85 cm. Tapaciranje: E30/5 - pjena 30Kg/m3 5cm obložena visokokvalitetnom medicinskom kožom. Težina: 100 kg. Konstrukcija je prmazana prahom na 210ºC. Proizvod s oznakom CE, proizveden u Španjolskoj.


Ginekološki pregledni ležaj
Trodjelni pregledni ležaj. Kromirana čelična konstrukcija. Ležaj bijele boje. Dimenzije: 180x60 cm, visina 78 cm. Držači za noge i okrugla posuda.

Držač role za papir za pregledne ležajeve TITANOX
Šifra
M600352/Q
Držač role za papir za pregledne ležajeve REXMOEBEL
Šifra
15.1.2644.00

Dvoslojna papirnata prekrivka

Šifra Dimenzije
14.0.2775.00 39cm×50m
14.0.2906.00 49cm×50m
14.0.1266.00 59cm×50m
14.0.2551.00 39cm×100m
14.0.0696.00 49cm×100m
14.0.0231.00 59cm×100m
Šifra Dimenzije
14.0.4547.00 39cm×50m
14.0.4338.00 49cm×50m
14.0.5605.00 59cm×50m
14.0.4549.00 39cm×100m
14.0.5417.00 43cm×50m
14.0.4337.00 59cm×100m

Šifra
FMED-Elefant
Kolica su vrlo sigurna za pacijenta i osiguravaju jednostavno rukovanje. Kolica su izrađena od čeličnih profila, presvučena antistatičkom praškastom bojom, otporna na UV zračenje, mehanička oštećenja i dezinfekcijska sredstva. Dva segmenta na ležećoj površini ispunjeni su HPL-om, propusnim za rendgenske zrake. Visina platforme madraca, Trendelenburg i anti-Trendelenburg se podešavaju uz podršku hidrauličkih stupova i reguliraju pomoću pedala s obje strane kolica. Kolica su opremljena ABS bazom, prostorom za stvari bolesnika i bocu kisika, 4 odbojnika, ručkama za guranje, 4 utora za IV stup a imaju integrirani teleskopski IV stup, držač za rolu papira i madrac debljine 8 cm, u vodootpornoj, perivoj i antialergijskoj navlaci koji se može skidati i stavljati na strecher. Kolica su opremljena zaštitnim bočnim ogradama s obje strane.
Kolica za prijevoz djece | JUMBO
Šifra
FMED-Jumbo

Šifra
FMED-Camel


Jumbo transportna kolica su jedinstveni proizvod, dizajniran za prijevoz djece. Jumbo strecher ima jako dobru pokretljivost i visoku funkcionalnost kao u najboljim kolicima za odrasle. Najmlađi pacijenti percipiraju bolničko okruženje kao manje prijeteće i ljepše kada su okruženi prijateljskim bojama i uzorcima kojima smo ukrasili naša kolica.
Transportna hidraulična nosila
Šifra
ECO-C3701
ECO-C3702
Opis
Podešavanje visine 50-90 cm
Ukupna dužina nosila: 198 cm
Podešavanje visine 46-84 cm
Ukupna dužina nosila: 198 cm
Transportna hidraulična nosila Ecopostural dizajnirana su za hitne intervencije i transport pacijenata u bolničkom okruženju. Izrađena su od visokokvalitetnih materijala. Okvir nosila napravljen je od čelične konstrukcije premazane bijelim epoksidnim premazom, pečenim na 250°C za dugotrajnost i otpornost. Širina ležaja: 62 cm. Udaljenost od tla: 16 cm. Podizna sklopiva ograda. Podizna sklopiva ograda. Kotači: promjer 125 mm, dva upravljiva, sva četiri opremljena s kočnicom Pomično uzglavlje: ručno se podiže do kuta od 60°. Težina nosila: 85 kg. Maksimalna nosivost: 135 kg. Držač infuzije: uključen. Dodatne opcije: držač za bocu s kisikom, ladica za pohranu.


Zbog svoje visoke funkcionalnosti može se prilagoditi individualnim potrebama bolničkih odjela. Ovaj proizvod je opremljen paletom od 2 dijela ispunjenom rendgenskim prozirnim HPL pločama. Konstrukcija je izrađena od čeličnih profila prekrivenih praškastim lakom, elektrostatična, otporna na ultraljubičasto zračenje, mehanička oštećenja, sredstva za dezinfekciju i čišćenje. Opremljen je sa: 4 plastična zaštitna odbojnika za zaštitu od udaraca; madrac koji se može skinuti, od poliuretanske pjene presvučen umjetnom kožom dostupan u različitim bojama; četiri kotača 200 mm, bez ostavljanja tragova, sa središnjim sustavom za kočenje; držač role papira. Podešavanje visine palete ostvaruje se nožnom hidrauličnom pumpom. Naslon za leđa, Trendelenburg i Reverse Trendelenburg položaji prilagođeni plinskim oprugama s međusobnim blokiranjem.
Kolica za pacijenta fiksne visine
Šifra
15.2.5668.00
Dimenzije: 200x75x80 cm. Težina 45 kg, nosivost: 150 kg. Kotačići od min 200 mm, opcionalno pojedinačno ili centralno kočenje. Dodaci: držač boce za kisik, stalak za infuziju, košara.

Kolica za prijevoz pacijenta s nosilima
Šifra
15.2.1283.00
Izrađena od obojenog cjevastog čelika. Odvojiva ležeća površina – tapecirana i prekrivena perivim plastičnim materijalom. Dimenzije: dužina 195 cm, širina 75 cm, visina 82 cm, nosivost: 120 kg.

Kolica za pacijenta JNEC-2L
15.2.4416.00
Kromirani okvir. Ležaj od perivog plastičnog materijala. Četiri kotačića Ø 10 cm. Dimenzije: 190×59×88 cm. Težina: 36 kg. Maks. težina pacijenta: 159 kg. Dodaci: stalak za infuziju, košara.

Podesiva po visini (50 – 90 cm) – hidrauličko podešavanje / podešavanje nožnom pedalom. Površina za ležanje(60X190cm); stražnji dio s ručnim upravljanjem – 70°. S/S bočne stranice podesive po visini sa svake strane, ručno upravljane. Ručke za guranje / povlačenje. S/S Držač za bocu s kisikom. Poliuretanski madrac s vodootpornom navlakom koja se može skinuti. 4 odbojnika (po jedan na svakom uglu), 4 kotača koji su opremljeni kočnicama Hidraulički mehanizam omogućuje podešavanje visine nosila na kojoj pacijent leži. Kolica
D-01
D-02
D-03
D-04
D-05
D-06
D-09
D-10
Radiotranslucentan | Okvir od nehrđajućeg čelika | Dim: 196x66x50/90 cm
Radiotranslucentan | Metalni okvir s epoksidnom završnom obradom | Dim: 196x66x50/90 cm
Okvir od nehrđajućeg čelika | Dim: 196x66x50/90 cm
Metalni okvir s epoksidnom završnom obradom | Dim: 196x66x50/90 cm
Okvir od nehrđajućeg čelika | Dim: 196x66x50/90 cm
Metalni okvir s epoksidnom završnom obradom | Dim: 196x66x50/90 cm
Okvir od nehrđajućeg čelika | Dim: 196x66x75 cm
Metalni okvir s epoksidnom završnom obradom | Dim: 196x66x75 cm





OP stolovi za oftamologiju, maksiofacijalnu kirurgiju, estetsku kirurgiju, dermatologiju i ostale mikrokirurške zahvate
ZATRAŽITE POSEBNU PONUDU U POTPUNOSTI
PRILAGOĐENU VAŠIM POTREBAMA
Certifikati i Brumaba kvaliteta
BRUMABA operacijski stolovi izrađuju se isključivo u Njemačkoj s posebnom pažnjom. Tvrtka BRUMABA posjeduje certifikat EN ISO 13485 i podliježe strogom sustavu upravljanja kvalitetom. Kao medicinski uređaji, operacijski stolovi testirani su prema sljedećim standardima:
• IEC 60601-1 “Medicinska električna oprema”
• IEC 60601-2-46 “Posebni zahtjevi za osnovnu sigurnost i funkcionalnost operacijskih stolova”
Osim toga, BRUMABA operacijski stolovi testirani su na biokompatibilnost i sigurnost dostupnog softvera. BRUMABA operacijski stolovi posebno su razvijeni prema zahtjevima medicinskih stručnjaka. Trenutna paleta proizvoda odražava dugogodišnje iskustvo u proizvodnji i praktičnoj primjeni. Svi BRUMABA operacijski stolovi proizvode se u Njemačkoj i stalno se usavršavaju što daje sigurnost da nove potrebe bolnica i ordinacija budu uvijek zadovoljene. BRUMABA operacijski stolovi predstavljaju visoke standarde kvalitete, uravnoteženu funkcionalnost i sigurnost u operacijskoj sali, čime dodatno pridonose učinkovitosti radnih procesa u operacijskoj sali.


Ovaj univerzalni i mobilni operacijski stol, kao što ime sugerira, predstavlja najraznovrsniji BRUMABA operacijski stol. Omogućuje fleksibilnu primjenu u ambulantnim zahvatima, i to u ortopediji, estetskoj i rekonstruktivnoj kirurgiji. Dio za noge podijeljen je na dva dijela, koji su zasebno podesivi. Funkcija "Airplane" omogućuje nagib operativnog polja prema kirurgu čime se štite njegova leđa prilikom zahvata. Gdje se Varius operativni stol može koristiti: Estetska plastična kirurgija; Dermatologija; Dermato-kirurgija; Ortopedija; Ambulantna kirurgija. Operacijski stol Varius otvara nove mogućnosti za interdisciplinarnu uporabu! Zbog svoje svestranosti, idealno je rješenje u ambulantnoj kirurgiji. Osigurava učinkovit i ekonomičan raspored operacija, bilo u klinici ili ordinaciji. Dug vijek trajanja i tehnologija koja zahtijeva minimalno održavanje čine ga pouzdanim alatom za svakodnevnu upotrebu. VARIUS operacijski stol nudi vrhunsku prilagodljivost i pouzdanost za različite kirurške zahvate, pružajući optimalne uvjete i pacijentima i kirurzima.


Tehničke karakteristike:
• Minimalna duljina: 1770 mm
• Maksimalna duljina: 1940 mm
• Ukupna širina: 555 mm
• Vlastita težina: 207 mm
• Maksimalno opterećenje: 300 kg

• Minimalna visina bez jastuka: 555 mm
• Maksimalna visina bez jastuka: 985 mm
• Visina jastuka: 65 mm
• Bočni nagib lijevo: 17°
• Bočni nagib desno: 17°
Multifunkcionalan i opremljen svim dodacima –od trodimenzionalno podesivog naslona za glavu i integriranih standardnih vodilica u okviru od nehrđajućeg čelika do integriranog nožnog prekidača za rad bez korištenja ruku. Naravno, opremljen je i pametnom funkcijom nazvanom »airplane« – za rad koji je posebno prilagođen za rasterećenje leđa. Područja primjene: Estetska plastična kirurgija; Dermatologija; Dermato-kirurgija; Endodoncija; Otorinolaringologija; Oralna i maksilofacijalna kirurgija. Brumaba PRIMUS utjelovljuje kvalitetu "Made in Germany" u svakom svojem detalju Potpuno je funkcionalan čak i za pacijente do 300 kg, a zahvaljujući kotačima s funkcijom glatkog kretanja može se pomicati lakoćom, čak i pod maksimalnim opterećenjem. Posebno tanak dizajn operacijskog stola PRIMUS, kao i posebni sustav vodilica integriranih u okvir od nehrđajućeg čelika, osiguravaju kirurzima da u sjedećem ili stojećem položaju imaju optimalan pristup pacijentu s maksimalnim prostorom za noge.

Tehničke karakteristike:
• Minimalna duljina: 1770 mm
• Maksimalna duljina: 1940 mm
• Ukupna širina: 555 mm
• Vlastita težina: 185 kg
• Maksimalno opterećenje: 300 kg
Vrhunska kvaliteta , ergonomija i udobnost osnovne su karakteristike Brumaba GENIUS operacijskog stola koji spaja vrhunsku izradu sa pametnim detaljima koji osiguravaju maksimalnu udobnost za kirurga i pacijenta. GENIUS je "Made in Germany", što znači najvišu kvalitetu, dugotrajnu konstrukciju od nehrđajućeg čelika i dodatno debelu podstavu za optimalnu udobnost i trajnost. Maksimalna sigurnost. Glavni oslonac za glavu na GENIUS operacijskom stolu može se podesiti u tri dimenzije, automatski se prilagođavajući promjenama položaja i težine. Stol se može fleksibilno prilagoditi kako bi omogućio ergonomsku i učinkovitu radnu poziciju. Područja primjene: Estetska plastična i rekonstruktivna kirurgija; Dermatologija i Dermato-kirurgija; ORL kirurgija; Rinoplastika; Maksilofacijalna kirurgija. Zahvaljujući elegantnom dizajnu, GENIUS operacijski stol omogućuje operaterima i asistentima udobnost uz dovoljno prostora za noge. Stol se može prilagoditi iz ležećeg u sjedeći položaj.

Tehničke karakteristike:
• Minimalna duljina: 1804 mm
• Maksimalna duljina: 1992 mm
• Ukupna širina: 565 mm
• Nosivost: do 250 kg

• Minimalna visina bez jastuka: 465 mm
• Maksimalna visina bez jastuka: 895 mm
• Visina jastuka: 65 mm
• Bočni nagib lijevo: 17°
• Bočni nagib desno: 17°


• Podesiva visina bez podstave: 465 - 895 mm
• Podesiva visina bez podstave: 525 - 815 mm
• Visina podstave: 65 mm
Velik broj dodatnih modula za sve operacijske stolove!
CADDY 4 U 1 - stolac, ležaj, transportna kolica i postoperacijski krevet
Multifunkcionalnost, mobilnost, moderna izvedba obilježja su CADDY višenamjenskog proizvoda. Caddy je 4-u-1 rješenje koje kombinira stolac, ležaj, transportna kolica i postoperacijski krevet, omogućavajući sigurno i udobno pozicioniranje te jednostavan transport pacijenata. Fiziološki optimalan položaj ležanja stabilizira krvni tlak pacijenta. Udobna podstava dostupna u 35 boja.
Položaj stolca - u ovom položaju pacijentima omogućavate jednostavan i siguran ulazak i izlazak iz CADDYja, čime se olakšava priprema za postupak ili oporavak. Chaiselongue položaj - Chaiselongue položaj nudi opuštenu i udobnu poziciju za pacijente koji se žele odmoriti nakon zahvata, osiguravajući im potpuni komfor. Trendelenburg položaj - ova klasična ležeća pozicija postavlja pacijentovu glavu u najnižu točku tijela, što povećava venski povrat krvi prema srcu. Ovaj položaj je važan za hitne mjere kod šok-stanja ili ortostatskog kolapsa.



Tehničke karakteristike:
• Minimalna duljina: 960 mm

• Maksimalna duljina: 1900 mm
• Minimalna visina bez podstave: 560 mm
• Maksimalna visina bez podstave: 1440 mm
• Ukupna širina: 660 mm
• Težina: 65 kg
• Maksimalna nosivost: 180 kg
Šifra HIRO OP.STOL
Zahvaljujući hidrauličkim i mehaničkim prilagodbama, stol može raditi u bilo kojem prostoru te ne zahtijeva pristup električnoj mreži. Veliki i lako upravljivi kotači sa središnjim kočnim sustavom osiguravaju izvrsnu pokretljivost i stabilnost stola. Središnja kočnica, smještena na strani uzglavlja, olakšava manevriranje i omogućuje brzo zaključavanje stola. Segmenti gornje plohe stola su propusni za rendgenske zrake, što omogućuje snimanje rendgenskih slika i nadzor pacijenta pomoću C-luka. Korištenje rendgenske kasete je vrlo praktično zahvaljujući tunelima postavljenima ispod uzglavlja, naslona i sjedišnog segmenta.

Tehničke karakteristike:
• Dimenzije: 2020 mm x 564 mm
• Raspon podešavanja visine (s madracem): 750 do 1050 mm
• Trendelenburg / obrnuti Trendelenburg nagib: - 25 ° / 25 °
• Podešavanje naslona: - 40 ° do 80 °
• Podešavanje segmenta za noge: 20 ° to 90 °
• Promjer kotača: 125 mm
• Podešavanje oslonca za glavu: 45 ° - 45 °
• Maksimalno dopušteno opterećenje: 230 kg

Električni kreveti | AQUILA II
Šifra
FMED-Comfort
FMED-Standard
Kreveti AQUILA II odgovor su na vrlo zahtjevno tržište medicinskih kreveta. Kupci i pacijenti očekuju jednostavne, funkcionalne i izdržljive krevete za sve vrste dijagnostike, praćenja i liječenja. AQUILA II se proizvodi u dvije različite konfiguracije, ovisno o potrebama kupaca.
COMFORT
Opremljen je sa 4 bočne stranice od polipropilena u boji po izboru, uklonjivo uzglavlje i uznožje izrađeno od polipropilena. Ukupna širina kreveta ispod 100 cm s odbojnicima na sva 4 kuta,4 kotača promjera 150 mm sa pojedinačnim kočnicama. Široki raspon podešavanja visine kreveta, uzglavlja,uznožja i koljena, CPR, TR, ATR te mnoštvom ostalih dodatnih funkcija.


Opremljen metalnim bočnim ogradama (bočnim šinama na 3/4 dužine kreveta ili bočnim šinama pune dužine). Uklonjivo uzglavlje i uznožje izrađeno od metalnih cijevi s HPL pločama iznutra ili od plastike s mogućnošću izrade personalizirane grafike. Ukupna širina kreveta 96 cm s odbojnicima olakšava manevriranje, čak i u uskim hodnicima, malim dizalima i uskim sobama, 4 kotačića promjera 125 mm sa pojedinačnim kočnicama.
Električni krevet | CONDOR
Šifra
FMED-Condor
Jednostavan, provjereni dizajnkrevet Condor ima tradicionalnu, iznimno izdržljivu i pouzdanu konstrukciju. Zahvaljujući unutarnjem okviru udobniji je za pacijente. Dostupan je u više verzija i može se uskladiti sa specifičnostima bolničkog odjela. Dostupne su 3 verzije: krevet s dva, tri ili četiri segmenta paleta. Krevetna paleta se puni žičanom mrežom ili po želji HPL pločama. Laka i jednostavna uporaba za korisnika i njegovatelje - paletni segmenti u Condor krevetu se podešavaju jednostavnim mehanizmima, a poluge se nalaze na lako dostupnim mjestima. Mehanizmi potpore za podešavanje pažljivo su odabrani, tako da je rukovanje segmentima jednostavno i bez napora.

TEDDY Bed junior pedijatrijski krevet
Šifra
FMED-Teddy
Teddy Bed je pedijatrijski krevet za stariju djecu, namijenjen za dječje odjele u bolnicama. Dizajniran je s posebnim naglaskom na sigurnost i specifične potrebe djece i roditelja.
Tehničke karakteristike:
• Ukupna duljina: 1966 mm
• Ukupna širina: 860 mm
• Duljina platforme za madrac: 1700 mm
• Širina madraca: 700 mm
• Raspon prilagodbe visine: 400-780 mm
• Promjer kotača: 125 mm
• Podešavanje naslona za leđa: 0-72°

• Podešavanje segmenta za bedra: 0-32°
• Podešavanje segmenta za potkoljenice: 0-22°
• Trendelenburg položaj: 0-13°
• Obrnuti Trendelenburg položaj: 0-13°
• Maksimalno dopušteno opterećenje: 180 kg
Usuglašenost s novim standardom EN 50637:2017 (dječji krevet)

DJEČJI električni krevet | SPARROW
Šifra
FMED-Sparrow
Bolnički krevet za malu djecu
15.1.5745.00
Visina ležišta se može prilagoditi vertikalno i pod kutem. Bočna ograda se može spustiti. 2 standardna kotačića i 2 s kočnicama. Dužina: 150 cm. Dužina ležaja: 139 cm. Visina: 137.50 cm. Širina: 79 cm.


Krevetić Sparrow ima posebnu konstrukciju koja njegovatelju olakšava rad bez obzira na visinu njegovatelja. Pozicija ležne površine s bočnom ogradom ispod madraca i konstrukcija krevetića na stupovima omogućava bolji pristup pacijentu. Bočnim ogradama se lako i glatko upravlja pomoću nožnih poluga. Bočne ograde dodatno su osigurane bravama koje sprječavaju slučajno spuštanje.
Električni krevet za njegu bolesnika | LT10
Šifra
LT10
Nosiva vanjska struktura izrađena od čeličnih profila. Okvir s četiri pomične sekcije izrađen je od čeličnih cijevi s poprečno postavljenim drvenim letvicama i vodilicama. Opremljen je s dva priključka za trapez i nosač infuzije. Sekcija za podizanje glave i sekcija za noge prilagodljive su putem dva električna motora na 24 V DC s kabelskim daljinskim upravljačem koji ima magnetski ključ za aktivaciju. Dio za stopala prilagodljiv je ručno pomoću zupčastog mehanizma. Dio za zdjelicu je fiksan. Uz krevet dolazi trapez s podiznom šipkom, ručkom i prilagodljivim remenom od najlona. Vertikalno podešavanje visine od otprilike 41 cm minimalne visine do 86 cm maksimalne visine. Trendelenburg položaj do 10° i anti-Trendelenburg položaj do 10°. Otpuštanje ograda moguće je putem gumba na uzglavlju. Uklonjivi dijelovi izrađeni od obojenih čeličnih cijevi s kotačima Ø 100 mm i kočnicom, te drvenim pločama kao završnom oblogom. Boja: Bež. Dimenzija ležaja: 200x90 cm. Ukupne dimenzije: 220x105 cm. Ukupna težina: 105 kg. Najveća nosivost: 180 kg.

Električni krevet za njegu bolesnika
Šifra
LT-M3
LT-M3A
Vanjska nosiva konstrukcija izgrađena od čeličnih profila. Opremljen s dva priključka za stup za podizanje pacijenta i za stalak za infuziju. Uz krevet dolazi montažni trapez s podesivim najlonskim remenom. Električni krevet podesiv po visini (38 - 79 cm) uz pomoć 2 24 V DC elektromotora. Trendelenburg i anti-Trendelenburg podešavanje do 10° uz pomoć žičanog upravljača, zahvaljujući neovisnom kretanju dvaju elektromotora integriranih u naslone. Stranice kreveta - vertikalne klizne, od aluminija, na vodilicama pričvršćene za naslone, s blokadom. Bočno otpuštanje pomoću gumba na stražnjoj strani. Uklonjivo uzglavlje i uznožje od obojene čelične cijevi prekrivene drvenim pločama i opremljene okretnim kotačićima Ø 100 mm s kočnicama. Dimenzija ležaja: 200 x 90 cm. Ukupne dimenzije: 215x102 cm. Ukupna težina: 98 kg. Najveća nosivost: 180 kg.

LT-M3A Električni krevet za osobe s demencijom i Alzheimerovom bolešću
Električni krevet podesiv po visini od 20 cm do 76 cm uz pomoć 2 24 V DC elektromotora - posebno niski položaj kreveta smanjuje mogućnost ozljede oboljeih osoba od demencije.

Šifra Širina kreveta
LT-120B 120 cm
LT-140B 140 cm
Električni krevet za pretile osobe - do 285 kg nosivosti. Krevet je opremljen s 4-dijelnom zglobnom podnicom s letvicama. Pomoću daljinskog upravljača moguće je prilagoditi podizanje naslona za leđa i naslona za noge kako bi pacijent mogao zauzeti najudobniji položaj. Trendellemburg i Anti-Trendellemburg funkcija. Krevet je opremljen kliznim aluminijskim ogradama, četiri rotirajuća kotača s parkirnom kočnicom te ugrađenom ručkom za pomoć pri ustajanju pacijenata. Dimenzija ležaja: 215 x 132 cm. Ukupna težina: 125 kg. Najveća nosivost: 285 kg.
Električni i zglobni krevet | NewCare Bariatric
Šifra NC BARIATRIC
LT-120B
Tehničke karakteristike:
• Pune dimenzije: 132 x 215 cm
• Dimenzije podnice: 120 x 191 cm
• Visina od tla: 36 do 76 cm
• Težina: 125 kg
• Nosivost: 285 kg
LT-140B
Tehničke karakteristike:
• Pune dimenzije: 152 x 215 cm
• Dimenzije podnice: 140 x 191 cm
• Visina od tla: 36 do 76 cm
• Težina: 135 kg
• Nosivost: 285 kg

Električni i zglobni krevet sa sustavom podizanja linearnih aktuatora (stupanj zaštite IP66). Ovaj model kreveta pomaže pri rješavanju problema skrbi, liječenja i sigurnosnih pitanja za pacijente do 250 kilograma. Šasija (okvir) kreveta izrađen je od čelika visoke otpornosti s epoksidnim premazom, kako bi se osigurala trajnost i čvrstoća. Linearni aktuatori sa zaštitom IP66. 320 kg sigurnosnog radnog opterećenja. 4 zaštitna odbojnika u svakom uglu. Dvostruki regresijski sustav, smanjuje pritisak u području zdjelice i rizik od dekubitusa. Bočne ograde izrađene od polipropilena sa zonom za hvatanje i sklopivim sustavom pomoću plinske opruge. Centralni sustav kočenja putem pedala smještenih u području uznožja i uzglavlja (2 + 2).
Madrac Klasik HR
Šifra
EUSP-01

Jezgra se sastoji od poliuretanske pjene. Visina madraca je 13 cm. Jezgra madraca presvučena je tkaninom koja sadrži 76% PES vlakna i 24% pamuka prošivena sa 100 g/m2 silikoniziranim poliesterskim vlaknima. Madrac je dvostran.
Madrac Memory Star
Šifra
EUSP-03

Izrađen je od visoko kvalitetne termoaktivne memory pjene čija visina je 5 cm u kombinaciji sa poliuretanskom pjenom visine 10 cm. Površina madraca je od visco-elastične, memory pjene što pozitivno utječe na cirkulaciju. Visina madraca je 17 cm.

Mehanički bolnički krevet | MILVA
Šifra
FMED-Milva
Ekonomičan, univerzalni bolnički krevet atraktivnog, modernog dizajna, paleta madraca s 4 dijela i hidraulično podešavanjem visine.

Madrac Klasik HR, Inko
EUSP-02

Jezgra se sastoji od hladno lijevane pjene. Visina madraca je 14 cm. Jezgra madraca presvučena je tkaninom STERIL koja je vodonepropusna - zrakopropusna, periva na 95°C, sterilizacija na 135°C. Madrac je dvostran

Sve modele madraca moguće je izraditi u svim dimenzijama. Svi naši proizvodi izrađeni su od materijala sa eko certifikatom.
Naš partner tvrtka Alech uvodi niz novih tehnoloških sustava za rješavanje različitih vrsta situacije u bolnicama, staračkim domovima i drugim ustanovama.
Sustavi su dizajnirani s najinovativnijim i najsuvremenijim dostupnim tehnologijama i za jednostavnu instalaciju i konfiguraciju.
Svi uređaji su s antimikrobnim materijalima za bolju kontrolu infekcija.
Ovim sustavima može se istovremeno upravljati bežičnim, WI-FI, sabirnim i lan vezama.
Kontaktirajte našu prodaju za izradu ponude prilagođene Vašim potrebama.
Vaš Kvantum -tim !


Samostojeći trapez
Šifra

Služi kako bi pomogao pacijentu pri ustajanju iz kreveta. Samostojeći je, što znači da je prikladan za sve vrste kreveta. Postolje je izrađeno od čelika obojanog bijelom bojom, a podesivi držač je kromiran. Na držaču je traka na kojoj visi trapez. Visina se može prilagođavati i preko kromiranog držača i trakom. Visina konstrukcije je od 182 do 191 cm. Nosivost je do 80 kg. Dimenzije postolja su 70 x 86 cm.
Lift za podizanje pacijenta
RI824 Električno podizanje do 150 kg
RI828 Električno podizanje do 200 kg
RI823 Hidraulična pumpa do 150 kg
Montažni trapez za krevet
RI827 Hidraulična pumpa do 200 kg Šifra MI094
Može se monitirati na bilo koji metalni krevet. Ø 30 mm; opterećenje do 75 kg.
Šifra


Lakirani čelični okvir. Pomicanje pomoću 4 kotača (promjera 10 cm). Dva kotača su opremljena kočnicama Mehanizam za otvaranje nogu s polugom sa sigurnosnom bravom. Gumb za zaustavljanje u nuždi. Udobne ručke. Posebno dizajnirane sigurne kuke za smještaj pojasa. Uz lift dolazi orma
Dimenzije 60 x 190 cm.
Unutarnja širina obruča 76 cm.
Kapacitet: 150 kg.


11.0.5720.00 Šifra
Tekstilna orma koristi se za transfer pacijenata iz kreveta u kolica i obrnuto.

Standardna orma za sve vrste liftova za podizanje pacijenta. Kapacitet: 180 kg.



Šifra Opis
D-68 nehrđajući čelik | visina: 150-280 cm 4 sigurnosne kuke
D-69 nehrđajući čelik | visina: 150-280 cm 2 sigurnosne kuke
D-70 nehrđajući čelik | visina: 130-210 cm 4 sigurnosne kuke
D-71
nehrđajući čelik | visina: 130-210 cm
2 sigurnosne kuke
D-72 aluminijski okvir | visina: 130-210 cm 4 sigurnosne kuke
D-73 aluminijski okvir | visina: 130-210 cm 2 sigurnosne kuke



Moretti | stalak za infuziju s 4 kuke, 5 kotačića
Šifra Opis
MI437 metalni | nehrđajući čelik | visina: 135-240 cm
MI427 plastično postolje | nehrđajući čelik | visina: 135-240 cm

Stalak za transfuzijsku vrećicu
Šifra D-76
Okvir od nehrđajućeg čelika (Inox AISI 304). Podesiva visina (70 – 100 cm) – ručno podešavanje.
Stalak za infuziju
Šifra
M600698
Kromirani čelik na 5 kotačića promjera 50 mm. Podesiva visina od 160 do 250 cm.

Stalak za infuziju
Šifra SUN-46104
Kromirani nehrđajući čelik na 5 kotačića od toga 2 s kočnicom Podesiva visina od 117 –208 cm.
Stalak za infuziju Zidni stalak za infuziju
Šifra
M600694
Inox,2 plastične kuke. Na kotačima.



Držač boca za urin
Šifra Opis
SUN-47310 Bijeli, metalni okvir, cca 22 cm
SUN-47330 Kromirani, cca 32 cm

2 sigurnosne kuke dužina:
D-75 4 sigurnosne kuke dužina: 50 cm


Infuzijski stalci za jedinice intenzivnog liječenja za infuzijske pumpe i medicinske uređaje
Infuzijski stalci za operacijske sale
Infuzijski stalci za MRI
Stalak za zavoje
Šifra D-76
Okvir od nehrđajućeg čelika (Inox AISI 304) na 4 kotačića od kojih su dva opremljena kočnicama

Infuzijski stalci za urologiju
Infuzijski stalci za pedijatriju

Držač boce za infuziju
Šifra 15.5.1186.00
Od nehrđajućeg čelika

ČETVERODIJELNI paravani
Šifra Opis
D10-73-4 nehrđajući čelik (Inox AISI 304) | bijeli/plavi | 240 X 170 cm | na kotačiće
M600826 kromirani čelik | bijeli | 191 X 170 cm | na kotačiće

DVODIJELNI paravani
Šifra Opis

D-82 nehrđajući čelik (Inox AISI 304) | bijeli/plavi | 120 X 170 cm | na kotačiće
M600825/M kromirani čelik | bijeli | 97 X 170 cm | na kotačiće


TRODIJELNI paravani
Šifra Opis
D-81 nehrđajući čelik (Inox AISI 304) | bijeli/plavi | 180 X 170 cm | na kotačiće
M600825 kromirani čelik | bijeli | 144 X 170 cm | na kotačiće
DRVENI paravan
Šifra
Dimenzije: 193x170 cm. Širina jednog panela: 64 cm. Težina: 10 kg. Drveni okvir orah, paneli od sanforiziranog pamuka. Nezapaljivo!

PT1-S Teleskopski zidni paravan s perivom bijelom PVC zavjesom
Šifra TOW020813
Teleskopska šipka paravana PT1-S izrađena je u cijelosti od nehrđajućeg čelika, sastoji se od četiri međusobno povezane, nepokretne i teleskopski proširive cijevi. Na zid se učvršćuje pomoću ugrađenog
Stepenice s DVA gazišta
Šifra Opis
D-89 kromirani čelik | 43x63x43 cm
15.5.0418.00 Čvrsta konstrukcija | 46×52×44 cm
M600851 kromirani čelik | čvrsto gazište | visina 42 cm
M600851P kromirani čelik | plastično gazište | visina 42 cm





JEDNODIJELNI paravan
Metalni bijeli okvir. Dimenzije: 90×180 cm.

nosača. Dolazi s perivom PVC zavjesom (oznaka ZZ-3) u bijeloj boji. Raspon dužine nosača: od 850 do 2.500 mm. Preporučena visina montaže: od 1.800 mm do 2.000 mm.

Stepenice s JEDNIM gazištem
Šifra Opis
D-88 nehrđajući čelik | 43x27x23 cm
M600850 kromirani čelik | čvrsto gazište | visina 24 cm
M600850P kromirani čelik | plastično gazište | visina 24 cm
D-90 Čvrsta konstrukcija | 35×45×18 cm
D-91 Čvrsta konstrukcija | 35×45×35 cm



Medicinska kolica | 8 ladica
Šifra

Izrađena su od nehrđajućeg čelika (Inox AISI 304). Kolica su opremljena s 8 prijenosnih ladica od nehrđajućeg čelika, ručkom za guranje, 4 kotača od kojih su dva opremljena kočnicama, te 4 odbojnika smještena iznad kotača na svakome uglu. Dimenzije: 50x75x100 cm.
Medicinska kolica | 4 ladice
Šifra

Konstrukcija zatvorenog tipa izrađena su od nehrđajućeg čelika (Inox AISI 304). Kolica su opremljena s 4 prijenosne ladice od nehrđajućeg čelika, stalak za infuziju, nosač za posude, teleskopsku policu, 4 kotača od kojih su dva opremljena kočnicama, te 4 odbojnika smještena iznad kotača na svakome uglu. Dimenzij: 50x70x85 cm.
Medicinska kolica | 2 ladice | 2 police

Izrađena su od nehrđajućeg čelika (Inox AISI 304). Uklonjiva ravna radna površina kolica i uklonjiva polica. Kolica su opremljena s 2 ladice, stalak za posudu za odlaganje, 2 ugrađene ručke, 4 kotača od kojih su dva opremljena kočnicama, te 4 odbojnika smještena iznad kotača na svakome uglu. Dimenzije: 50x70x85 cm
Medicinska kolica | 2 police

Izrađena su od nehrđajućeg čelika (Inox AISI 304). Kolica su opremljena s 1 ladicom, 4 kotača od kojih su dva opremljena kočnicama, te 4 odbojnika smještena iznad kotača na svakome uglu. Dimenzije: 50x70x84 cm.
Medicinska kolica | 6 ladica
Šifra
Izrađena su od nehrđajućeg čelika (Inox AISI 304). Kolica su opremljena s 6 prijenosnih ladica od nehrđajućeg čelika, ormarom s dvije uutarnje police i ormarićem, ručkom za guranje, 4 kotača od kojih su dva opremljena kočnicama, te 4 odbojnika smještena iznad kotača na svakome uglu. Dimenzije: 50x75x100 cm.

Medicinska kolica | 4 ladice
Šifra

Izrađena su od nehrđajućeg čelika (Inox AISI 304). Kolica su opremljena s 4 prijenosne ladice, s 2 ručke za guranje, s 4 kotača od kojih su dva opremljena kočnicama, te 4 odbojnika smještena iznad kotača na svakome uglu. Dimenzije: 50x75x85 cm.
Medicinska kolica | 2 ladice | 2 police i organizatorom
Šifra
Izrađena su od nehrđajućeg čelika (Inox AISI 304). Ravna radna površina kolica i polica dolaze s obodom na sve četiri strane. Kolica su opremljena s 2 ladice od nehrđajućeg čelika, 2 prijenosna spremnika za otpad, stalak za posudu, nosač s organizatorom (8 plastičnih ladica smještenih u dva reda), ugrađene ručke, 4 kotača od kojih su dva opremljena kočnicama, te 4 odbojnika smještena iznad kotača na svakome uglu. Dimenzije: 50x70x85 cm.

Medicinska kolica | 1 velika ladica | 5 manjih ladica
Šifra D-27
Izrađena su od nehrđajućeg čelika (Inox AISI 304). Kolica su opremljena s 5 manjih prijenosnih ladica i jednom velikom ladicom, ormarom s dvije uutarnje police, ručkom za guranje, 4 kotača od kojih su dva opremljena kočnicama, te 4 odbojnika smještena iznad kotača na svakome uglu. Dimenzije D-27 medicinskih kolica: 50x75x100 cm. Dodatne mogućnosti: mogućnost odabira dimenzija, broja ladica i polica.

Medicinska kolica | 2 police
Medicinska kolica | 3 police
Izrađena su od nehrđajućeg čelika (Inox AISI 304). Tri poli ce dolaze s obodom. Kolica su opremlje na s 2 ugrađene ruč ke, 4 kotača od ko jih su dva opremlje na kočnicama, te 4 odbojnika smještena iznad kotača na sva kome uglu.

Izrađena su od nehrđajućeg čelika (Inox AISI 304). Dvije police dolaze s obodom. Kolica su opremljena s 2 ugrađene ručke, 4 kotača manjeg promjera od kojih su dva opremljena kočnicama


Medicinska kolica | 2 police
Šifra Dimenzije (cm)
D-40 40 x 60 x 80
D-41 50 x 70 x 85
Izrađena su od nehrđajućeg čelika (Inox AISI 304). Dvije police dolaze s obodom. Kolica su opremljena s 1 ugrađenom ručkom, 4 kotača od kojih su dva opremljena kočnicama.
Medicinska kolica | 2 police
Šifra Dimenzije (cm)
M600866/08 40 x 60 x 80
M600867/08 50 x 70 x 80
Dvije police s uzdignutim rubovima. Na kotačima. Konstrukcija od inoxa


Medicinska kolica | 1 polica
Šifra
D-44
Izrađena su od nehrđajućeg čelika (Inox AISI 304). Kolica su opremljena s 4 kotača od kojih su dva opremljena kočnicama. Dimenzije: 50x100x110 cm.

Medicinska kolica sa staklenim policama
S KOTAČIĆIMA
Šifra Dimenzije
15.2.0858.00 50 x 60 cm
15.2.0313.00 50 x 80 cm
S FIKSNIM NOGAMA
Šifra Dimenzije
15.2.0857.00 50 x 60 cm
15.2.1241.00 50 x 80 cm


Medicinska kolica | 2 police
Šifra Dimenzije (cm)
D-42 40 x 60 x 80
D-43 50 x 70 x 84

Izrađena su od nehrđajućeg čelika (Inox AISI 304). Dvije police dolaze s ravnom površinom. Kolica su opremljena s 4 kotača od kojih su dva opremljena kočnicama
Medicinska kolica | 3 police
Šifra Dimenzije (cm)
M600866/3 40 x 60 x 80
M600867/3 50 x 70 x 80
Tri police s uzdignutim rubovima. Na kotačima. Konstrukcija od inoxa
Medicinska kolica | 2, 3 i 4 police
Šifra Dimenzije (cm)
15.2.2664.00 37 x 46 x 77
15.2.2730.00 37 x 46 x 85
15.2.0498.00 37 x 46 x 112
S kotačićima i odvojivim policama.


Medicinska kolica od emajliranog čelika
S KOTAČIĆIMA
Šifra Dimenzije
15.2.2110.00 50 x 60 cm
15.2.2774.00 50 x 80 cm
S FIKSNIM NOGAMA
Šifra Dimenzije
15.2.2769.00 50 x 60 cm
15.2.2773.00 50 x 80 cm
Kolica za instrumente | drvena | 3 police
Drvena kolica s kotačićima i 3 police. Lak na bazi vode. Dimenzije: 56x70x74,5 cm. Kapacitet: 8 kg.
Dvije čelične police. Kapacitet: 20 kg po polici.

Drveni okvir je dostupan u nekoliko boja:



Mayo stol za instrumente
Šifra Dimenzije (cm)
D-45 40 x 60 x 80
D-46 50 x 70 x 80
Izrađeni su od nehrđajućeg čelika (Inox AISI 304). Ravna radna površina zaštićena je sa svih strana obodom. Stol je opremljen s 4 kotača od kojih su dva opremljena kočnicama Regulacija visine: (ručna): u rasponu od 80 do 140 cm.

Mayo stol za instrumente
Šifra Dimenzije (cm)
D-49 40 x 60 x 80/120
D-50 50 x 70 x 80/120
Izrađeni su od nehrđajućeg čelika (Inox AISI 304). Ravna radna površina zaštićena je sa svih strana obodom. Stol je opremljen s 4 kotača od kojih su dva opremljena kočnicama. Regulacija visine (ručna): u rasponu od 90 do 120 cm.

Mayo stol za instrumente VEĆE površine
Šifra
M600481
Čelična konstrukcija i odvojiva tacna. Na kotačima. Visina podesiva od 90 do 115 cm. Dimenzije podloška: 70x45x1,7cm.
Mayo stol za instrumente MANJE površine
Šifra
M600482
Čelična konstrukcija i odvojiva tacna. Na kotačima. Visina podesiva od 90 do 115 cm. Dimenzije podloška: 62x44x1,7cm.


Mayo stol za instrumente
Šifra Dimenzije (cm)
D-47 40 x 60 x 80
D-48 50 x 70 x 80
Izrađeni su od nehrđajućeg čelika (Inox AISI 304). Uklonjiva ravna radna površina zaštićena je sa svih strana obodom. Stol je postavljen na stabilnu bazu s 4 kotača od kojih su dva opremljena kočnicama Hidraulička regulacija visine uz pomoć nožne pedale: u rasponu od 90 do 140 cm.

Sonnenburgov stol
Šifra
15.2.1608.00
Stalak od kromiranog čelika Odvojiva tacna izrađena od nehrđajućeg čelika, s povišenim rubom sa svake strane. Mogućnost podešavanja visine. Dimenzije: 49×69 cm, visina 94-137 cm.
Mayov stol | 02.480.00
Šifra
15.2.2193.00
Izrađen od nehrđajućeg čelika. Visina od 85 do 115 cm. Četiri kotača Ø 50 mm. Dimenzije odvojive tacne: 70×45×3 cm.
Stalak s odvojivom posudom
Šifra Dimenzije (cm)
D-79 35 x 35 x 80
D-80 70 x 35 x 80
Fiksna visina. Kolica s odvojivom posudom izrađena su od nehrđajućeg čelika (Inox AISI 304). Na vrhu kolica nalazi se odvojiva posuda. Kolica su postavljena na bazu s 5 kotačića. Dimenzije: 35x35x80 cm.




Šifra
15.2.4487.00
Kolica s jednim vratašcima i tri ladice. Ladice su izrađene su od plastike. Okvir od aluminija. Postranične ploče i stražnja ploča Massiv-Dekor, otporne na udarce. Četiri kotačića Ø 125 mm (dva s kočnicom. Vanjske ploče izrađene od nehrđajućeg čelika. Sustav za centralno zaključavanje. Dimenzije: visina 96 cm, dužina 56 cm, uključujući ručku i kotačiće, širina 48 cm.

Šifra
TIT.5006-M
Funkcionalan dizajn. Potporna baza izrađena od medijapana Roletne s ABS-om s aluminijskim završetkom, klizne. Pet ladica na izvlačenje s vodilicama. Unutar jedne ladice stoji 5 prozirnih malih ladica. Svaka ladica može se unutar odjeljka podijeliti u 7 mjesta pomoću separatora. Veličina male ladice: 90x400x80 (v) mm. Stol za pisanje.

Kolica za reanimaciju
H-MED 56-F
Šifra
15.2.5373.00
Sadrži četiri ladice s oznakama. Kompaktna veličina omogućava lako kretanje uz bolesničke krevete. Opremljena nagibnom drškom za platformu s defibrilatorom s četiri ladice, stalkom za infuziju i pločom za KPR. Aluminijski okvir, postranične ploče i stražnja ploča Massiv-Dekor otporne na udarce. Gornja
ploča i prednje ploče ladica zaštićene plastičnim materijalom, opremljene pregradama. Četiri kotačića Ø 125 mm (dva s kočnicom) pružaju sigurnost i omogućuju lako kretanje. Vanjski dijelovi izrađeni od nehrđajućeg čelika. Dimenzije: dužina: 56 cm, širina: 54 cm, visina: 95 cm.
Kolica za previjanje | 4 ladice
Šifra
Radna površina od perivog polistirena otpornog na udarce. 3 ladice visine 14,5 cm i 1 ladica visine 31,5 cm. Stol za pisanje na izvlačenje. Mogućnost zaključavanja. Na 4 kotačića. Dimenzije: 70x64x104 cm.

Ležaj za bebe RexMöbel
Kolica za previjanje | 5 ladica

Okvir od čelika lakiranog bojom u prahu. Četiri kotačića s kočnicama na stražnjim nogama. Madrac je uključen (debljina 5 cm s kožnom presvlakom). Dimenzije košare: 50×70 cm.
Radna površina od perivog polistirena otpornog na udarce. 5 ladica visine 14,5 cm. Stol za pisanje na izvlačenje. Mogućnost zaključavanja. Donja baza s integriranim odbojnikom imaju plavi profil otporan na udarce. Montira se na 4 kotača, promjera 125 mm od kojih 2 s kočnicom. Dimenzije: 70x64x104 cm.

Dvije police. Dimenzije: 90x60x80 cm. Konstrukcija od inoxa. Uključuje: držač za boce, kanta za otpad, držač i zdjela fi 32 cm.
Stolić za previjanje beba RexMöbel SVI OSTALI MODELI KOLICA (INOX, ABS, PE...) NA UPIT!
Stolić za previjanje beba

Za jedno dijete. Dimenzije: 105×70×86 cm.

Kolica za previjanje

Šifra Opis
1 dijete
2 djeteta
Metalne nožice. S ladicom; od laminiranih ploča.
Dimenzije: 70×70×95 cm (za jedno dijete); 70×140×95 cm (za dva djeteta).

Kolica za čisto rublje | D-51
Šifra

Izrađena su od nehrđajućeg čelika (Inox AISI 304). Dolaze s 5 polica koje su sa tri strane zaštićena obodom. Kolica su opremljena s 4 kotača od kojih dva dolaze s kočnicom, te 4 odbojnika smještena iznad kotača na svakome uglu. Dimenzije: 40x60x130 cm.
Kolica za nečisto rublje | D-54

Izrađena su od nehrđajućeg čelika (Inox AISI 304). Kolica su ograđena rešetkastom ogradom i opremljena su s dvije ručke i 4 kotača od kojih dva dolaze s kočnicom, te 4 odbojnika smještena iznad kotača na svakome uglu. Dimenzije: 100x60x90 cm.
Kolica za rublje
15.2.1262.00
Dimenzije: 44×119×108 cm. Četiri kotačića s kočnicama Tri police i dvije vreće za rublje Struktura jamči čvrstoću i funkcionalnost. Okvir izrađen od obojenog cjevastog čelika

Kolica za rublje | tri platnene vreće
Sklopiva kolica za rublje s okvirom od čelika lakiranog bojom u prahu. Vreća za rublje izrađena je od platna i može se pričvrstiti za okvir Dimenzije: dužina 56 cm, širina 48 cm, visina: 94 cm. Četiri antistatička kotačića.
Kolica za čisto rublje | D-52

Izrađena su od nehrđa jućeg čelika (Inox AISI 304). Dolaze s 5 polica koje su sa tri strane za štićena obodom. Kolica su opremljena s 4 kota ča od kojih dva dolaze s kočnicom, te 4 odbojnika smještena iznad kotača na svakome uglu. Dimenzijee: 50x70x120 cm.
Kolica za čisto i nečisto rublje | D-52

Izrađena su od nehrđajućeg čelika (Inox AISI 304). Kolica dolaze s ručkom za guranje, tri police zaštićene obodom sa svih strana te fiksnim nosačima na kojima je postavljena uklonjiva vreća za nečisto rublje. Kolica su opremljena s 4 kotača od kojih dva dolaze s kočnicom, te 4 odbojnika smještena iznad kotača na svakome uglu. Dimenzije: 50x100x90 cm.

Kolica za rublje

Kromirani čelični okvir na kotačiće. Promjer nosača 46 cm, visina 95 cm. Vreće za rublje se lako skidaju i peru. M600840 | 1 vreća za rublje. M600841 | 2 vreće za rublje.

Kolica za čisto rublje | D-53

Izrađena su od nehrđajućeg čelika (Inox AISI 304). Dolaze s 3 police i bočnom ručkom. Kolica su opremljena s 4 kotača od kojih dva dolaze s kočnicom, te 4 odbojnika smještena iznad kotača na svakome uglu. Dimenzije: 40x80x110 cm.
Kolica za nečisto rublje | D-57
Izrađena su od kromom obloženog okvira. Na njima se nalazi poklopac od ABS plastike sa sistemom otvaranja na pedalu. Kolica su postavljena na 4 kotača. Dimenzij: 50x60x110 cm.
BAG Vreća za nečisto rublje


Izrađena od prljavo bijelog platna. Težina tkanine: 280gr/m2. 100% pamuk. Perivo / 90°C. Dimenzije (+/-): 50 x50 x visina 120 cm. Izuzetno otporna na često pranje.
Kolica za nečisto rublje | D-60
Izrađena su od nehrđajućeg čelika (Inox AISI 304). Kolica su opremljena s 3 kotača od kojih jedan dolazi s kočnicom. Dimenzije: 50x90 cm.

Kolica za nečisto rublje | D-61

Izrađena su od nehrđajućeg če lika (Inox AISI 304). Na konstruk ciju kolica postavljena je uklonji va vreća za prljavo rublje. Kolica su opremljena s 4 kotača od kojih dva dolaze s kočnicom. Dimenzije: 50x50x90 cm.
Ormari za lijekove i instrumente
Šifra D-66 D-67
Ormari za lijekove i instrumente dolazi u dvije varijante – s metalnim okvirom i epoksidnim premazom ili s okvirom od nehrđajućeg čelika (Inox AISI 304). Ormar dolazi s dvostranim staklenim ili metalnim vratima te s metalnim ili staklenim policama. Dimezije: 35x60x170 cm. Donji dio ormara dolazi s jednom metalnom policom i dvostranim metalnim vratima (D-67).


Šifra
Ormari za lijekove i instrumente
Šifra
Ormar za lijekove i instrumente od emajliranog čelika.
M600271 | Dimenzije: 75x37x164cm. 3 police gore iza kaljenog stakla. 2 police dolje iza metala. Bravice dolje i gore.
M600280 | Dimenzije: 79x36x186cm. 3 police gore iza kaljenog stakla. 2 police dolje iza metala. Bravice dolje i gore.


Ormari za lijekove i instrumente
Dvokrilni ormar lakiran bojom u prahu.
15.4.0835.00 | Staklena vrata s bravom i staklene police. Dimenzije: 90×40×180 cm.
Težina: 85 kg.
15.4.0729.00 | Gornji dio: dvokrilna staklena vrata; donji dio: vrata od čeličnog lima. Brave na vratima.
Staklene police.
Dimenzije: 90×40×180 cm
Težina: 80 kg.


Ormar drveni, 3 ladice, staklena vrata Šifra
15.4.5504.00
Rubovi ABS 18 mm (2 mm). Furnirani paneli. Metalne noge s mogučnošću niveliranja. Veličina: 180x90x40 cm .

Ormar za instrumente i lijekove
Šifra Dimezije (cm)
15.4.0623.00 45×45×180
15.4.1326.00 45×60×180
15.4.0502.00 60×45×180
15.4.1242.00 60×60×180
15.4.0825.00 90×45×180
Medicinski ormar sa 60 pretinaca i 5 polica

5 unutarnjih polica i dvoja unutarnja vrata. Vanjska vrata laminirana melaminom. ABS rubovi. Na svakim vratima po jedna stalaža sa podesivim odjeljcima. Zaključavanje vrata. Dimenzije 100 x 60 x 195 (v) cm. 10100A | Sa sigurnosnim ormarom za lijekove.


Jednokrilni drveni zidni ormarić za lijekove
15.4.1336.00 90×60×180 Šifra Opis
Drveni, sa staklenim vratima i policama. Jednostruki.

Ormarić sa stolićem za stomatološku ordinaciju
Šifra
15.4.0842.00
Konstrukcija od čelika lakiranog bojom u prahu. Staklene bočne strane i staklena vrata s bravom, kotačići s kočnicom. Dimenzije: 76×51×76 cm.

15.4.0841.00 Drvena vrata | 45×29×60 cm
15.4.0978.00 Drvena vrata | 60×29×60 cm
15.4.0624.00 Staklena vrata |45×29×60 cm
15.4.1183.00 Staklena vrata | 60×29×60 cm
Ormarić za lijekove ili kemikalije
15.4.1457.00
staklene bočne strane, staklena vrata s bravom, staklene police
15.4.1141.00 metalna vrata s bravom, metalne bočne strane i police
Zidni ormarić za lijekove ili kemikalije: od emajliranog čeličnog lima sa. Dimenzije: 50×30×70 cm.


Arhivski ormari sa kliznim vratima
Šifra
AO MAT 10015
Iznimno izdržljive metalne izvedbe. Klizna vrata izuzetno praktična jer ne zahtjevaju dodatni prostor oko vas. Zaključavanje cilindar bravom. Unutrašnjost opremljena policama koje su podesive po visini. Nosivost svake police je 70 kg. Dimenzije: 195x120x45 cm.
Ormar kartotečni “MAT”

KO MAT 4
Iznimno izdržljive metalne izvedbe. Namjenjene odlaganju visećih mapa ili dokumenata A4 formata u ležečem položaju. Zaključavanje centralnom cilindar bravom, sa mehanizmom protiv prevrtanja. Teleskopske vodilice. Boja tijela: svjetlo siva, antracit siva, crna. Boja vrata: žuta, žuto zelena, crvena, rubin crvena, plava, nebesko plava. Dimezije: 133 x 62 x 41 cm | 4 ladice.


Drveni ormar za odjeću
Šifra Opis
15.4.0762.00 Jednokrilni | 45×60×180 cm
15.4.1779.00 Dvokrilni | 60×60×180 cm
15.4.1786.00 Trokrilni | 90×60×180 cm

Arhivski ormari model AO MAT
Šifra Opis
AO MAT 10001 100×80×38 cm | 1 polica
AO MAT 10002 120×92×42 | 2 police
AO MAT 10003 180×80×38 | 3 police
AO MAT 10004 195×92×42 | 4 police
AO MAT 10005 195x120x42 | 4 police
Iznimno izdržljive metalne izvedbe. Dvokrilna vrata s trosmjernim zabravnim sustavom, zaključavanje cilindar bravom. Unutrašnjost opremljena policama koje su podesive po visini, nosivost svake police 70 kg. Izvedba bez vrata posebno prilagođena uredima sa skućenim prostorom. Boja tijela: svjetlo siva, antracit siva, crna. Boja vrata: žuta, žuto zelena, crvena, rubin crvena, plava, nebesko plava.
Kartotečna kolica
TIT.4007-R


Radna površina od perivog polistirena otpornog na udarce. Ladice su opremljene vodilicama za držanje A4/A3 kartona. Najviše 20 kartona po ladici, ukupno 40 u obje. Mogućnost zaključavanja. Na 4 kotačića. Dimezije: 70x64x104 cm.
Garderobni ormar GO MAT
Šifra Opis
GO MAT 1 Jednodijelni | 30×50×180 cm
GO MAT 2 Dvodijelni | 60×50×180 cm
GO MAT 3 Trodijelni | 90×50×180 cm
Čvrste metalne konstrukcije. Standardno zaključavanje sa cilindar bravicom. Standardna unutarnja oprema: polica ispod koje je prečkica sa kukicama; opcionalna razna oprema na poseban upit. Vrata sa prorezima za provjetravanje i okvirom za oznaku. Ormari se isporučuju u RAL 7035 (sivo) ;nudimo veliki izbor standardnih boja.


Stolci za čekaonicu Iso Colorplast
Šifra Opis
15.3.3835.01 Dvosjed | 100 x 44 x 88 cm | bordo
15.3.3835.02 Dvosjed | 100 x 44 x 88 cm | plava
15.3.3835.03 Dvosjed | 100 x 44 x 88 cm | siva
15.3.3654.01 Trosjed | 150 x 44 x 88 cm | bordo
15.3.3654.02 Trosjed | 150 x 44 x 88 cm | plava
15.3.3654.03 Trosjed | 150 x 44 x 88 cm | siva
15.3.3706.01 Četverosjed | 200 x 44 x 88 cm | bordo
15.3.3706.02 Četverosjed | 200 x 44 x 88 cm | plava
15.3.3706.03 Četverosjed | 200 x 44 x 88 cm | siva
Sjedalo od otpornog plastičnog materijala s čvrstim okvirom od čelika lakiranog bojom u prahu. Dostupne boje: bordo, plava ili siva.

Stolci za čekaonicu
Šifra Opis
MS-002-13 Dvosjed | 110 x 50 x 75 cm
MS-002-12 Trosjed | 166 x 50 x 75 cm
MS-002-11 Četverosjed | 220 x 50 x 75 cm
Naslon i sjedalo PVA. Konstrukcija metalna. Boje: siva, crvena, plava, bijela.

Stolci za čekaonicu s drvenim sjedalom
Šifra Opis
15.3.5608.00 Dvosjed | 120 x 47 x 82 cm
15.3.5609.01 Trosjed | 175 x 47 x 82 cm
15.3.5610.00 Četverosjed | 230 x 47 x 82 cm
Okvir od čelika lakiranog bojom u prahu. Drvena sjedala. Otporni, jednostavni za održavanje.

Stolci za čekaonicu
Šifra Opis
15.3.0847.00 Dvosjed | 110 cm
15.3.0846.00 Trosjed | 170 cm
15.3.0518.00 Četverosjed | 210cm
Bijela boja, obojeni okvir. Plastična sjedala.

Klupa za čekaonicu
Šifra
15.3.2598.00
Metalna sjedala, dužina 200 cm, bijela.


Plastični okrugli stolac bez naslona
Šifra
M600390/P
M600389/P
Promjer crnog sjedišta 32 cm. Plastična konstrukcija. M600390/P | bez kotača M600389/P | s kotačima

Laboratorijski stolac bez naslona
Šifra Opis
15.3.1696.01 fiksne noge
15.3.1075.01 na kotačiće
Kromirani stolac s bijelom podstavom sjedišta. Podesiva visina 42-54 cm. Osnovna boja: bijela. Dostupne boje: narančasta, crna, bordo, bež.

Radna stolica 1030 ZON
Bez naslona, plinski podizač, plastična baza. Ukupna visina:49 - 59 cm. Ukupna širina:58 cm. Visina sjedišta:49 - 59 cm. Širina sjedišta:38 cm.
Dubina sjedišta:38 cm.

Okrugli stolac bez naslona
Šifra
M600389/G
S kotačima i hidraulikom. Promjer crnog sjedišta 32 cm. Inox konstrukcija.
Stolac na okretanje s plinskom pumpom
Plastično postolje s plinskom pumpom 5 nogu s kotačićima. Visina podesiva od 43 do 55 cm.

Laboratorijski stolac Moretti
Aluminijsko postolje promjera 50 cm. Podstavljeno sjedište promjera 32 cm.
Kromirani klip za plinski podizač, 20 cm. Visina: 53-73 cm.

Radna stolica 1030 Zon Medica
Presvučeno sjedalo, naslon od eko kože, mekani kotači s kočnicom, kromirani plinski podizač, kromirana baza. Ukupna visina: 50 - 62 cm. Širina sjedišta: 46 cm.

Okrugli stolac s kotačima

Hidraulični mehanizam za podešavanje visine te perivim sjedištem. Podesiv po visini: 45 – 58 cm.

Stolac na okretanje
Šifra
15.3.1856.00
15.3.0767.00
Plastično postolje s 5 kotačića. Visina podesiva od 43 do 55 cm. Sjedalo od nehrđajućeg čelika.
15.3.1856.00 | Bez plinske pumpe
15.3.0767.00 | S plinskom pumpom

Stolac na okretanje s okruglim sjedalom KaWe
Šifra Boja
15.3.2325.01 crna
15.3.2325.02 plava
15.3.2325.03 siva
Visina sjedala: 450570 mm. Sigurnosna pneumatska opruga s ručicom za podizanje i spuštanje. Kotačići prikladni za kretanje po tepihu.

Radna stolica 1290 Zon
1290 ZON
Bez naslona, plinski podizač, plastična baza. Ukupna visina: 46 - 59 cm. Ukupna širina: 60 cm.
Visina sjedišta: 46 - 59 cm. Širina sjedišta: 35 cm.

Laboratorijski stolac s naslonom
Šifra Opis
15.3.2206.01 fiksne noge
15.3.2536.01 na kotačiće
Kromirani stolac s bijelom podstavom sjedišta i naslona. Podesiva visina 42-54 cm. Stolac s naslonom na kotačiće je s plinskom pumpom. Dostupne boje: bijela, narančasta,crna,bordo, bež.

Radni stol za liječnike
15.3.0503.00 Šifra M600301
S ormarićem i četiri
ladice s bravom Metalne noge u boji. Dimenzije: 65×77×130 cm.


Uredski stolac Panther
Šifra PANTHER
Viši i širi naslon podesiv po visini, plinski podizač, plastična baza.
Ukupna visina: 100 - 113 cm. Ukupna
širina: 60 cm. Visina sjedišta: 44 - 57 cm.
Širina sjedišta: 47 cm. Dubina sjedišta: 45 cm.

Uredski stolac Texas Multi
Šifra TEXAS MULTI
Visoki naslon, plastični fiksni rukonasloni, multi block mehanizam, plinski podizač, kromirana baza, dostupno u crnoj boji. Ukupna visina: 104112 cm. Ukupna širina: 68 cm. Visina / širina / dubina sjedišta: 47 - 55 cm / 49 cm / 49 cm.

Uredski stolac Panther ASYN
Šifra PANTHER ASYN
Viši i širi naslon podesiv po visini, asynchro mehanizam: ručkom podešavanje nagiba naslona i sjedala, plastična baza. Ukupna visina: 102117 cm. Ukupna širina: 63 cm. Visina sjedišta: 49 - 62 cm. Širina sjedišta: 47 cm. Dubina sjedišta: 46 cm.
Tri ladice s bravom. Okvir od emajliranog čelika. Dimenzije: 120x70x80 (v) cm.

Radni stol za medicinske sestre
Šifra 15.3.0638.00
Četiri ladice s bravom Metalno postolje u boji. Dimenzije: 65×78×115 cm.

Stolac na okretanje
Šifra XENIA

Stolac “Torino”
Šifra Opis
15.3.1120.00 crni | tekstil
15.3.1088.00 sivi | tekstil
15.3.0587.00 bijeli | skaj
Visoki naslon. Tekstil ili skaj. Podešavanje visine

Ergonomsko sjedalo i naslon, rukonasloni podesivi po visini Odvojeno podešavanje nagiba naslona i nagiba sjedišta stolice. Plinski podizač, plastična baza. Ukupna visina: 106 - 119 cm. Ukupna širina: 68 cm. Sjedište: visina 48 - 61 cm; širina 50 cm; dubina 46 cm.

Stolac “Nova Easy”
Šifra Opis
15.3.5625.00 bijeli | skaj
15.3.5623.00 crni | tekstil
15.3.5624.00 sivi | tekstil
Tekstil ili skaj. Na kotačiće.

Stolac s naslonom Shell
Šifra
Stolac bez rukonaslona, model Lucia
Konferencijski stolac LUCIA/KROM

Široko, udobno sjedalo bez naslona za ruke. Dimenzije: širina sjedala: 46 cm; dubina sjedala: 44 cm; visina sjedala: 41 cm; visina naslona: 39 cm. Kromirani okvir. Dostupne boje: bijela, narančasta,crna,bordo, bež, zelena.
Stolac s naslonom
15.3.4192.00 Šifra
Kromirana čelična konstrukcija, pjena naslona 25 mm, pjena sjedala 30 mm. Ukupna visina: 84 cm. Ukupna širina: 55 cm. Visina sjedišta: 48 cm. Širina sjedišta: 47 cm. Dubina sjedišta: 43 cm.


Plastificiran, čelični okvir s naslonima za ruke, pjena naslona: 30 mm, pjena sjedala: 30 mm. Ukupna visina: 82 cm. Ukupna širina: 55 cm. Visina sjedišta: 48 cm.
Širina sjedišta: 47 cm. Dubina sjedišta: 43 cm.

Konferencijski stolac 1120 TC
Stolac s naslonom, lakiran
15.3.1127.09 Šifra Opis
Kromirani okvir. Presvlaka od umjetne kože. Širina sjedala: 46 cm, dubina: 44 cm Ukupna visina 80 cm, visina naslona 39 cm. Protuklizna površina na nogama. Dostupne boje: bijela, zelena,, smeđa,bež, crna, siva.
Kromirani čelični okvir, punjenje sjedala i naslona debljine 40 mm. Ukupna visina:84 cm. Ukupna širina: 55 cm. Visina sjedišta: 49 cm. Širina sjedišta: 47 cm. Dubina sjedišta: 43 cm.

Sigurnosni sef, model ZAT21R-K
15.3.0588.00 Bez rukohvata
15.3.0991.00 S rukohvatom Šifra
Vanjske dimenzije: 330x450x385 mm. Unutarnje dimenzije: 40x380x292 mm.

Težina: 39 kg , V: 27 l. Broj polica: 1. Certifikati: Sigumosni razred B (EN14450). Modeli ZAT izrađeni su iz dvostruke stijenke s vatrootpornom izolacijom prema DIN4102. Zaključavanje: Mehanička sigurnosna brava, 2 ključa (Certificirana brava A kategorije, EN1300, VdS kl.I). Boja RAL 7035.
Sigurnosni sef, model ZAT23R-K

Vanjske dimenzije: 600x450x385mm. Unutarnje dimenzije: 500x380x292mm. Težina: 61 Kg , V: 55 l. Broj polica: 1. Certifikati: Sigumosni razred B (EN14450). Modeli ZAT izrađeni su iz dvostruke stijenke s vatrootpornom izolacijom prema DIN4 102. Zaključavanje: Mehanička sigurnosna brava, 2 ključa (Certificirana brava A Kategorije, EN1300, VdS Kl.I). Boja RAL 7035.
Elektrostatsko nanošenje praškaste bijele boje na okvir; skaj presvlaka na sjedištu i naslonu. Mogućnost slaganja u visinu. Dimenzije: 88x44x56 cm.

Protuprovalni sef, stupanj I

Vanjske dimenzije: 280 x 450 x 442 mm. Unutarnje dimenzije: 230 x 400 x 310 mm. Težina: 85 kg . Volumen: 29l Cerifikati: Stupanj sigurnosti I prema EN1143-1,VdS , ECB:S, VSO,a2p Vatrootpornost prema DIN4102. Zaključavanje: Mehanička sigurnosna brava Cawi,2 ključa (VdS class 1,EN1300), zaključavanje u 5 točaka. Mogućnost fiksiranja u pod i/ili zid.
Sigurnosni i protuprovalni sefovi, veliki

Protuprovalni sef, stupanj I, Wertheim. Vanjske dimenzije: 565x545x442mm. Unutarnje dimenzije: 515x495x310mm. Težina: 155 kg Volumen: 79l. Certifikati: Stupanj sigurnosti I EN1143-1, VdS, ECB: S, VSO, a2p, vatrootpornost prema DIN4102. Zaključavanje: Mehanička sig. brava Cawi, 2 ključa (VdS class 1, EN1300), s pripremom za fiksiranje i spajanje na alarmni sustav.
Profesionalni hladnjaci dostupni u 1 ili 2 raspona postavki, dizajnirani i razvijeni za pohranjivanje najboljih sanitarnih i bioloških termoosjetljivih proizvoda kojima je potrebna točna kontrola temperature skladištenja. Asortiman Fiocchetti dostupan je ili s ECT-F termostatom ili s ECT-TOUCH kontrolerom. Sva oprema ima atraktivan i moderan dizajn, a poboljšane performanse poboljšale su skladištenje medicinskih proizvoda. DOBAVLJIVO U SVIM DIMENZIJAMA.
Medicinski hladnjak - MEDIKA
(+2 / +15 °C) - 100 - 1500 l
Šifra Veličina
FIO-MED-100l 100 l
FIO-MED-250l 250 l
FIO-MED-500l 500 l


Medicinski hladnjak - MEDIKA 2T
(+2 / +15 °C) - 280 - 1500 l
Šifra Veličina
FIO-MED2T-280l 280 l
FIO-MED2T-400l 400 l
FIO-MED2T-500l 500 l


Rashladni uređaj - VISION
(-15 / -20 °C) - 400 - 700 l
Šifra Veličina
FIO-VIS-400l 400 l
FIO-VIS-700l 700 l
FIO-VIS2T-500 500 l


Rashladni uređaj - SUPERARTIC
(-20 / -40 °C) - 250 - 700 l
Šifra Veličina
FIO-SUPA-250l 250 l
FIO-SUPA-400l 400 l
FIO-SUPA-700l 700 l


Medicinski hladnjak - LABOR
(+2 / +15 °C) - 100 - 1500 l
Šifra Veličina
FIO-LAB-250l 250 l
FIO-LAB-400l 400 l
FIO-LAB-500l 500 l


Medicinski hladnjak/zamrzivačLABOR 2T (+2 / +15 °C ; -10 / -24 °C)
Šifra Veličina
FIO-LAB2T-280l 280 l
FIO-LAB2T-400l 400 l
FIO-LAB2T-500l 500 l


Rashladni uređaj - FREEZER
(-10 / -20 °C) - 140 - 1500 l
Šifra Veličina
FIO-FRE-140l 140 l
FIO-FRE-250l 250 l
FIO-FRE-1500l 1500 l


Rashladni uređaj - SUPERPOLO
(-10 /-45 °C) - 130 - 480 l
Šifra Veličina
FIO-SUPP-130l 130 l
FIO-SUPP-220l 220 l
FIO-SUPP-480l 480 l

Profesionalni farmaceutski i medicinski hladnjakHippocrates (0 / +15 °C) - 100 - 400 l
Šifra Veličina
BLO-775003 100 l
BLO-775004 250 l
BLO-775001 400 l


Profesionalni farmaceutski i medicinski hladnjak u koji se mogu pohraniti lijekovi, virusna cjepiva, kao i krv i druge ljudske tekućine. Razvijen je u 3 veličine (Modeli 400, 250 i 100), svi dostupni u verzijama s punim vratima i staklenim vratima.
Rashladni uređaj
ULTRA 540 (-40 / -86 °C) - 540 l
Šifra Veličina
BLO-775002 540 l
Inovativno rješenje za hlađenje koje je dizajnirano za ekstremne temperature, od -40°C do -86°C, zadovoljavajući stroge zahtjeve laboratorija i medicinskih ustanova . Ultra 540 koristi ekološki prihvatljive rashladne tvari R290 i R170, što svjedoči o predanosti održivosti. Ovaj vrhunski rashladni uređaj besprijekorno kombinira performanse, sigurnost i ekološki osviješten dizajn.

Prijenosni farmaceutski
hladnjak - Mobimed 50 (-5 / +10 °C) - 540 l
Šifra Veličina
BLO-758A024 50 l

Prijenosni farmaceutski hladnjak, prilagodljiv globalnim naponima izmjenične struje i 12V DC naponu. Sadrži kompresorski rashladni krug s dinamičkom distribucijom zraka. Prijenosan, ali robustan, ovaj hladnjak postavlja standarde za prijevoz i pohranu farmaceutskih proizvoda, nudeći neusporedivu pouzdanost i sigurnost profesionalcima u pokretu.
Uređaj za hlađenje otpada Waste Cooler
Šifra
BLO-757060

Dizajniran kako bi spriječio neugodne mirise i pojednostavio proces upravljanja otpadom. Poklopac s plinskim amortizerom osigurava lako ubacivanje otpada u kantu. Rashladna jedinica se montira s desne strane te hlađenjem usporava razgradnju otpada i smanjuje neugodne mirise koji se pritom oslobađaju. U uređaj stane jedna kanta za smeće.

Mini hadnjak Dometic, DM 50
NTE D, 50L, antracit sivi
Šifra Veličina
12.0.5833.00 50 l
Bešumni termoelektrični minibar s ladicom. Dizajn nagrađen za izvrsnu iskoristivost. Kapacitet 50 litara sa automatskom izvlačivom ladicom s mogućnošću podešavanja. Termoelektrični mini bar, boja antracit. Razred potrošnje: A+. LED rasvjeta.

Medicinski hladnjak
Dometic DS 600
Šifra
12.0.5856.00

Zapremnina od 52 L. Elektronska regulacija temperature (Fuzzy Logic). Senzor za otvaranje. Standardna LED rasvjeta. Reverzibilna vrata. Hladnjak može biti ugradbeni ili stajati samostalno.
Dimenzije (ugradbeni): 55 x 49 x 49 cm.
Dimenzije (samostalni): 59 x 49 x 49 cm
Prijenosni hladnjak, 25 l
Šifra Opis
12.0.0541.00 Hladnjak
12.0.2489.00 Uložak 200 ml
Medicinski hladnjak
Dometic DS 301 H
03.4.5649.00



Idealno rješenje za bolnice i domove zdravlja za čuvanje osjetljivih lijekova na temperaturi od 2 do 8°C. Magnetsko zatvaranje vrata. Standardna LED rasvjeta. Zvučni signal nakon 20 sek. upozorava da su vrata predugo otvorena. Prikaz posljednjih postavki minimalne i maksimalne temperature. Unutarnji ventilator izjednačava temperaturu i sprječava stvaranje leda. Pladnjevi s prozirnom prednjom pločom. Digitalni termometar koji prikazuje stvarnu unutarnju temperaturu. Zapremnina: 27 L (DS 301 H). Dimenzije (27L): 58×42×39 cm; težina: 15 kg.

D-64 Kolica za prijevoz hrane
Šifra
D-64
Kolica za prijevoz hrane izrađena su od nehrđajućeg čelika (Inox AISI 304). Kolica su opremljena s jednom bočnom ručkom, 12 utora za pladnjeve i s 4 kotača od kojih su dva opremljena kočnicama.

D-65 Kolica za prijevoz hrane
Šifra
D-65
Kolica za prijevoz hrane izrađena su od nehrđajućeg čelika (Inox AISI 304). Kolica su opremljena s jednom bočnom ručkom, 24 utora za pladnjeve, dvoja vrata i s 4 kotača od kojih su dva opremljena kočnicama.
Kolica za prijevoz pokojnika
Šifra Opis
D-13 bez kotača
D-15 4 kotača s kočnicama
Izrađena su od nehrđajućeg čelika (Inox AISI 304). Površina za ležanje sa obodom od čeličnog lima (60X190cm), odvodna rupa. Dimenzije: 190x60x75 cm.



Kolica za prijevoz pokojnikahidraulički podesiva visina
Šifra
D-14

Izrađena su od nehrđajućeg čelika (Inox AISI 304). Podesiva visina (50 – 900 cm) – hidrauličko podešavanje / podešavanje nožne pedale. Površina za ležanje sa obodom od čeličnog lima (60X190cm), odvodna rupa. Dimenzije: 190x60x75 cm. 4 kotača koji su opremljeni kočnicama. Dimenzije: 190x60x50/90 cm.

Pregledna svjetiljka OLOA 101
Šifra
08.0.5414.00
Visokokvalitetna stropna svjetiljka koja se okreće za 360°. Maksimalna jačina svijetlosti na udaljenosti od 1 m: 100.000 lx. Podesiva svjetlina: 10 - 100%. Promjer glave: 500 mm. Broj LED dioda: 63 (bijela i žuta). Podesivo fokus. CRI:> 95. Podesiva temperatura boje: 3800 - 4800K. Dubina osvjetljenja: 150 cm.

Svjetiljka za operacijske dvorane LED500
Šifra
08.0.5415.00
Svjetlina: 40.000 - 140.000 lx. Promjer svjetiljke: 500 mm. Podesiva temperatura boje: 3800 - 4800K. Kontrola svjetline: izravno pomoću dezinfekcijske ručke. Promjer osvijetljene površine: 160 - 320 mm. Broj LED dioda: 48. Upravljanje: na 4,3-inčnom zaslonu osjetljivom na dodir pored svjetiljke. Snaga: 100W. Indeks prikaza boja (Ra): 95. Testno područje bez sjene.

Pregledna lampa na kotačićima, samostojeća | TITANOX
Šifra M600733
Fleksibilna pregledna lampa s reflektorom izrađenim od aluminijske legure, savitljivim u svim smjerovima. Postolje od nehrđajućeg čelika s 5 kotačića. Podesiva visina od 100 do 150 cm. Žarulja nije uključena.
Pregledna svjetiljka KS-LA-6S
08.0.5411.00
LED svjetiljka za preglede sa stalkom, ručku je moguće ukloniti i sterilizirati. Svjetiljka je jačine 6W i temperature boje oko 4800-5500K.


Pregledna svjetiljka KS-Q7
08.0.5408.0
Svjetiljka za operacijske dvorane Minston LED700
Šifra

Kontrola svjetline. Dug radni vijek sa 7 LED svjetiljki. Intenzitet svjetla (na udaljenosti od 0,5 m): 56 000 luksa. Temperatura boje: 5.500 K.

Svjetlina: 50.000 - 170.000 lx. Promjer svjetiljke: 700 mm. Temperatura boje: 4300 - 4800 K. Kontrola svjetline: izravno pomoću dezinfekcijske ručke. Promjer osvijetljene površine: 160 - 350 mm. Broj LED dioda: 80. Upravljanje: na 4,3-inčnom zaslonu osjetljivom na dodir pored svjetiljke. Snaga: 100W. Indeks prikaza boja (Ra): 95. Testno područje bez sjene.
Svjetiljka za operacijske dvorane KS-Q10
08.0.5416.00 Šifra
08.0.5409.00
10 LED svjetiljki s radnim vrijekom od 50,000 sati. Temperatura boje: 4-5,000K. Intenzitet svjetla (udaljenost od 1 m): 25 000 luksa. Širina osvjetljenja (udaljenost od 1m): 20 cm. Potrošnja energije: 12 W.

Mobilna halogena svjetiljka za preglede KS-Q35
08.0.5397.00
Halogena žarulja s dugačkom fleksibilnom drškom. Stalak s postoljem na kotačiće. Kontrola svjetline. Intenzitet svjetla: 30 000 luksa. Temperatura boje: 4500 K


Mobilna halogena svjetiljka za preglede ID
08.0.5399.00
Pomična glava, podesiva visina. Kontrola svjetline. Intenzitet svjetla: 12.000 – 20.000 luksa. Temperatura boje: 3000 – 4000 K.

Stolna svjetiljka s lupom NKL-01
Šifra Opis
08.0.3384.00 svjetiljka
08.0.5392.00 žarulja


Trostruko povećanje; leća promjera 125 mm. Fluorescentna žarulja promjera 205 mm; 230 V / 22 W. Podesivi poklopac koji štiti od ogrebotina. Fleksibilan potporni mehanizam.
Reflektor za preglede GS 300 LED

Šifra Opis
WA-44412 stolni / zidni
WA-44452 na stalku s kotačima
Jedno bijelo LED svijetlo koje uz značajnu uštedu električne energije pruža snažnije osvjetljenje od halogene žarulje. Jednostavno sklapanje i održavanje. Gumb za uključivanje na senzor. 100-240 V, 50-60 Hz AC. Vijek rada: 50 000 sati, LED tehnologija . 20.000 luksa, 5500 K. Dostupan u više modela: na stalku s kotačima, stolni ili zidni.
Svjetiljka s lupom Ring LED
Šifra
08.0.5391.00
Svjetiljka RING LED sa 6 LED žarulja i Waldmann lećom ra svjetlo na područje pregleda. Uvećanje bez iskrivljenja do samog ruba lupe. Vijek trajanja LED žarulja je više od 50 000 sati. Temp. boje: neutralna bijela, 4000 K. Kućište od anodiranog aluminija i zaštitom od crne akrilne plastike. Fleksibilna metalna drška. te IP20; zaštitni razred II.Mrežni kabel dužine 2,3 metra i Euro utikač.

Reflektor za preglede GS 600 LED

Šifra Opis
WA-44612 stolni / zidni
WA-44602 na stalku s kotačima
Tri bijela LED svijetla na širokoj glavi s ugrađenom ručkicom za lakše pozicioniranje glave pružaju jače i kontrolirano osvjetljenje. Uključivanje i podešavanje intenziteta preko senzora osjetljivih na pokret. LED svijetla pružaju znatno jače svijetlo od halogenih žarulja dok istovremeno štede električnu energiju. 50.000 luksa, 5500 K. Vijek rada: 50 000 sati.
Samostojeća lupa sa LED osvjetljenjem
Šifra AS6527
Lampa s povećalom, koje ima iznimnu stabilnost, jer ima odgovarajuće utegnuto postolje, što slični dizajni nemaju! Lampa ima vrlo nisku potrošnju energije i dug životni vijek LED žarulje (oko 4000h). Koristi se za tretmane manikure i pedikure, trajnu šminku ili depilaciju. Ima antirefleksno staklo i ne uzrokuje bolove u očima pri radu. Idealno za kozmetičke salone, stomatološke ordinacije, veterinarske ordinacije, i druge usluge.
Tehničke karakteristike:
• 5 puta povećanje
• 60 LED dioda
• 560 lumena
• 230 V
• snaga 8W
• 90cm dug krak
• promjer 12 cm objektiva
• Dimenzije: 55 * 43 * 14
75 * 23 * 10


Lupa sa LED osvjetljenjem - povećanje 5x
Šifra AS6482

Lampa ima vrlo nisku potrošnju energije i dug životni vijek LED žarulje (oko 4000h). Također se koristi za tretmane manikure i pedikure, za trajnu šminku ili za uklanjanje dlačica. Idealno za kozmetičke salone, stomatološke ordinacije, veterinarske ordinacije, itd. Komplet sadrži: žarulja, kabel za napajanje, lupa.
Tehničke karakteristike:
• 60 LED dioda
• 560 lumena
• snaga 8W
• 90cm dužina kraka
• promjer 12cm leće
• dimenzije: 75 * 2
Šifra AS4428
Lupa za povećanje 5 dioptrija. Također se koristi uz tretmane manikure i pedikure, trajnu šminku, uklanjanje dlačica. Ima visoku vidljivost, antirefleksno staklo i LED lampe kojae osvjetljavaju jarko bijelo svjetlo bez izazivanja bolova u očima na radnom mjestu. Idealno za kozmetičke salone, stomatološke ordinacije, veterinarske ordinacije, itd.
Tehničke karakteristike:
• 5 dioptrija
• napajanje: 22 W
• napon 220-240 V / 50 Hz
• Dimenzije: 79 * 27 * 16



Laboratorijska centrifuga LMC-3000
Šifra
BS-010208-AAA
BS-010208-EK
Moderna stolna centrifuga male brzine dizajnirana za rad s mikrotest pločama i centrifugalnim epruvetama do 50 ml. Ovaj uređaj ima široku primjenu u laboratorijima biomedicinskog profila.
Tehničke karakteristike:
• Maksimalni kapacitet: 300 ml
• RPM: 100 - 3000 okretaja u minuti
• Maksimalni RCF: 1610 xg
• Vrijeme rada: 1-90 (prikaz, stručni)
• Odabir prikaza RPM/RCF: RPM
• Dimenzije: 235x420x495 mm
• Napajanje: 220-230 V / 50-60 Hz
• Težina bez rotora: 11,8 kg


Laboratorijska centrifuga MSV-3500
Šifra
BS-010210-TAH
Raspon kontrole brzine 300–3,500 rpm (zavisno o opterećenju). Namještanje vremena 0–60 min / non-stop. Zaslon LCD, 2 x 16 znakova. Vrijeme ubrzanja 3 sekunde. Orbita 4 mm. Maksimalno op terećenje 0.2 kg. Maksimalni neprekidni rad 8 sati. Dimenzije 180x170x145 mm. Masa 2.6 kg. Mikroprocesorska kontro la brzine i vremena. LCD zaslon prikazu je 2 linije vrijednosti: postavljenu i trenut nu vrijednost vremena i brzine.
Platforme uključene:
SV-4/30 - za 4 x 50 ml (30 mm) tube
SV-10/10 - za 10 x 10 ml (12 mm) tube

SV-16/8 - sa 16/8/8 priključaka za 1.5/0.5/0.2 ml mikrotest tube
SV-8/15 - za 8 x 15 ml (16 mm) tube
Medico Plus laboratorijska centrifuga
Šifra
03.3.5763.00
Najpopularniji model sada je dostupan s motorom bez četkica, sigurnosnom blokadom vrata, digitalnim indikatorom brzine i mjeračem vremena.
Tehničke karakteristike:
• S kutnim rotorom (8-cijevi), elektronika kontrolirana mikroprocesorom, VFD kontrola brzine, zeleni LED zaslon.
• Brzina ± 10 RPM, timer 99 minuta
• Najveća brzina: 4000 okretaja/ min; maksimalna RCF (relativna centrifugalna sila): 2270g.
• Dimenzije: 325x370x280 mm.

Laboratorijska centrifuga Microspin 12
Šifra
BS-010213-AA1

Kompaktna stolna centrifuga idelalna za biomedicinske laboratorije. Koristi se za ekstrakciju RNA/DNA uzoraka, sedimentaciju bioloških komponenti i kemijsku analizu mikrouzoraka. Zaslon istovremeno prikazuje vrijeme centrifugiranja, namještenu te trenutnu vrijednost brzine, relativnu centrifugalnu snagu (RCF).
Tehničke karakteristike: Raspon kontrole brzine: 100–14,500 rpm ( pomak 100 rpm). RCF: 50–12,400 × g. Digitalno namještanje vremena: 1–30 min ( pomak 1 min). Ubrzanje 14,500 rpm ( 20 sekundi). Usporavanje: manje od 10 sekundi. LCD display: 2 linije. Sigurnost: dijagnostika rotora izvan balansa s prikazom upozorenja te automatskim zaustavljanjem. Dimenzije: 200 × 240 × 125 mm. Masa: 3.5 kg. Dolazi u setu sa rotorom MSR-12 - rotor sa 12 mjesta za tubice 1.5/2 ml i adapterima: A-02 adapter (12 komada za tubice 0.2 ml) i A-05 adapter (12 komada za tubice 0.5 ml).
Laboratorijska stolna centrifuga Servospin
03.3.3901.00
Centrifuga s kutnim rotorom 12×20 ml, jednostavna za upotrebu, praktičnog dizajna, veliki LED zaslon. Elektronika kontrolirana mikroprocesorom, kratki ciklusi, poklopac se zatvara jednom rukom
Tehničke karakteristike:
• Maksimalna brzina: 4.000 okr/min
• Maksimalna sila ( RCF ): 2325 g
• Dimenzije: 320×350×280
• Težina: cca 9,5 kg

Vodena kupelj NB 9
Šifra
NB 9
Tehničke karakteristike:
Volumen spremnika. 9.5l; korisni volumen: 7l. Raspon temperature: ambijentalna +5°C / 99.9°C. Programabilna mikroprocesorska PID kontrola sistema. Temperaturna varijacija <40°C: +/- 0.2°C. Programabilni PID upravljački sustav mikroprocesora. Temperaturna fluktuacija: +/- 0.1°C. Digitalni prikaz temperature i vremena. Odbrojavanje: 1 minuta do 99,9 sati i držanje pozicije. Odgođeno pokretanje timera: 1 minuta do 99,9 sati. Unutrašnjost: nehrđajući čelik. Unutarnje dimenzije: 240 x 300 x 145 mm. Vanjske dimenzije: 320 x 405 x 275 mm.
Magnetna mješalica s grijanjem MSH-300
BS-010302-OAA
Tehničke karakteristike:
Raspon brzine: 250–1,250 rpm. Maksimalan volumen: 15 litara. Raspon temperature: +30°C do +330°C. Temperaturna uniformnost na grijačoj ploči: +/-3°C. Vrijeme grijanja do 330°C: 15 min. Promjer plohe: 160 mm. Dimenzije: 190 x 270 x 100 mm. Masa: 2.9 kg.


Magnetna mješalica s grijanjem MSH-300i
BS-010302-OAA
BS-010309
Dodatna oprema:
Tehničke karakteristike: Raspon brzine: 100–1,250 rpm (10 rpm pomak). Maksimalan volumen: 20 litara. Raspon temperature: +30°C do +330°C (1°C pomak). Temperaturna uniformnost na gri jačoj ploči: +/-3°C. LCD zaslon. Vrijeme grija nja do 330°C: 11 min. Promjer plohe: 160 mm. Dimenzije: 190 x 270 x 100 mm. Masa: 3.2 kg.
Držač temperaturne sonde - BS-010309-FK Vanjska temperaturna sonda - BS-010309-BK

Mali laboratorijski inkubator
BS-010309-BK Šifra
03.3.3081.00
Za 12 petrijevih zdjelica ili više epruveta za uzimanje krvi, kompaktan, čvrsto kućište. Vanjske dimenzije: 310×155×168 mm. Dimenzije unutrašnjosti: 220×120×168 mm Raspon temperature: 25-45 stupnjeva, točnost: +/- 1 stupanj.

BS-010309-BK

BS-010309-FK

Šifra
ND 4
ND 12
Destilatori iz ND serije koriste rashladni uređaj za kondenziraciju vode, a zatim koriste unaprijed zagrijanu vodu kako bi se smanjilo vrijeme vrenja kipuće vode. Produljeni životni vijek s nižim operativnim troškovima osiguravaju se uz pomoć ugrađenog magnetskog omekšivača vode, koji eleminira kalcifikacije u sustavu. LED zaslon pokazuje sve potrebne vrijednosti. Komponente od nehrđajućeg čelika. Siguran rad osigurava se elektroničkom kontrolom razine vode, s alarmom i automatskim isključivanjem u slučaju nedostatne opskrbe vodom. Slično tome, neuobičajeni pad tlaka vode daje iste rezultate i odmah se oglašava alarm. Unutarnji materijal nehrđajući čelik; vanjski materijal aluminij s poliesterskim praškastim premazom. Garancija: 2 godine. Podržana stručna instalacija.

ND 4 4 l/h 8 l 40 l/h 3 x 1000 W 3 faze, 50/60 Hz
ND 12 12 l/h 24 l 120 l/h 3 x 3000 W

82x39,5x65 40 kg
82x39,5x71 45 kg
UVR-M uređaj za UV recirkulaciju zraka
Šifra
UVR-Mi uređaj za UV recirkulaciju zraka
BS-040105-AAA Šifra
UVR-M je primjenjiv za UV recirkulaciju zraka i inaktivaciju u istraživačkim laboratorijima, sobama s oboljelima od zaraznih bolesti, čekaonice ambulantnih bolesnika odjela, operacijske sale i veterinarske stanice. Uređaji pružaju potpunu zaštitu od izravnog UV zračenja. Uređaj može biti fiksiran na dva načina: fiksiranje na zid (standardni) ili montaža na pokretni stativ (opcija). UV izvor radijacije: 1 lampa – 25W baktericidna, TUV25WG13 UV-C. UV razina radijacije 15 mW / cm2 / sec. Produktivnost protočnosti zraka 14 m3/sat. Dimenzije 110x135x660 mm. Masa 3.4 kg.Napajanje 230 V, 50 Hz ili 120 V, 60 Hz. Potrošnja (230V / 120 V) 125 VA (540 mA) / 160 VA (1.3 A ).

BS-040110-AAA
UVR-M je primjenjiv za UV recirkulaciju zraka i inaktivaciju u istraživačkim laboratorijima, sobama s oboljelima od zaraznih bolesti, čekaonice ambulantnih bolesnika odjela, operacijske sale i veterinarske stanice. Uređaji pružaju potpunu zaštitu od izravnog UV zračenja. Uređaj može biti fiksiran na dva načina: fiksiranje na zid (standardni) ili montaža na pokretni stativ (opcija).
UVR-Mi je snažniji model UV protoka zraka za čišćenje s 2 UV lampe. Korisnik je kompletno zaštićen od izravnog UV zračenja. 2 načina rada: kratko vrijeme (pod kontrolom timera) i kontinuirani rad. Naznaka vijeka trajanja UV lampe (radno vrijeme). UV izvor radijacije: 2 lampe – 25W baktericidna, TUV25WG13 UV-C. UV razina radijacije 30 mW / cm2 / sec. Produktivnost protočnosti zraka 14 m3/sat. LCD zaslon. Timer 1 min–24 sata / non–stop. Automatski prekidač ON/OFF. Detekcija neispravne lampe. Dimenzije 110x130x660 mm. Masa 3.4 kg. Napajanje 230 V, 50 Hz. Potrošnja snage 110 W (0,5 A).

Šifra
NBL 84i
NBL 124i
NBL 164i
NBL 214i
NBL 254i
NIMBUS modeli vaga EU proizvođaca Adam Equipment iz Velike Britanije s kapacitetom od 80 g do 250 g i očitanjem preciznisti 0.0001 g. Robusna metalna izvedba koja štiti unutrašnjost vage od ekstremnih uvjeta okoline. NIMBUS modeli nude višestruki izbor vagaonih jedinica te tzv “custom unit” za kompleksne vagaone kalkulacije. Mjerenje gustoće tekućina i krutina je vrlo jednostavno s ugrađenim programom koji korisnika vodi kroz cijeli proces kalkuliranja. Aplikacija “animalno / dinamičko vaganje” s digitalnim filterom smanjuje efekte kretanja vagaonog objekta te pospješuje točnost vaganja. Vage posjeduju RS232 i USB sučelje te je omogućen GLP ispis vremena, datuma te ostalih potrebnih elemenata. Aplikacije: vaganje, brojanje komada, postotno vaganje, dinamično / animalno vaganje, određivanje gustoće. Interna kalibracija. Očitanje: 0.0001g. Ponovljivost: 0.00015g. Linearnost (+/- ): 0.0002g. Mjerne jedinice: g, mg, ct, GN, oz, ozt, dwt. Mjerna ploha: fi 90 mm. Vrijeme stabilizacije: 3 sekunde. Sučelje: RS232, USB. LCD display sa pozadinskim osvjetljenjem te 20 mm visokim znamenkama. Rad pri temperaturama od 0°C do 40°C. Zaštita od utjecaja okoline: komora dimenzija 165x145x240mm. Dimenzije: 220x340x344mm. 3 godine jamstvo.
NBL 84i | 80 g (kapacitet)
NBL 124i | 120 g (kapacitet)
NBL 164i | 160 g (kapacitet)
NBL 214i | 210 g (kapacitet)
NBL 254i | 250 g (kapacitet)


Šifra
ABL 125
ABL 225

Motorizirane pipete (elektronske jednokanalne), Gilson Pipetman M
Šifra
F81013
F81022
F81017
F81015
F81024
F81023
F81014
F81016

Motorizirana pipeta koja aspirira i dispenzira uzorke bez primjene ikakve sile. Robusna, lagana i ekstremno udobna pipeta novije generacije. Pipeta ima mogućnost zaključavanja volumena. 4 načina pipetiranja: pipetiranje, repetativno pipetiranje, reverse mode, mix mode. Klasifikacija točnosti i preciznosti: bolja od propisanog ISO 8655.
Lako čitljiv LCD zaslon. Tipke s kodom u boji omogućuju brzo prepoznavanje najcešće korištenih tipki. Indikator visine te podesive nožice. Zatvoreni tip tipkovnice štiti vagu od prljavštine i prolijevanja. Ispisi od vage prikazuju datum i vrijeme u skladu s GLP. Opcija ZERO TRACKING. Selektivno digitalno filtriranje smanjuje efekte vibracija i utjecaja okoline. Uključen AC adapter. Očitanje: 0,01 mg / 0,1 mg. Mjerna ploha (304 nehrđajući čelik): fi 80 mm. Mjerne jedinice: mg, g. Vrijeme stabilizacije: 6s. Sučelje: RS-232. Interna automatska kalibracija. Radni uvjeti okoline: 15°do 30 °C. ABS kućište. Zaštitna komora: 171 x 162 x 225 mm. Ukupne dimenzije: 215 x 345 x 345 mm. Aplikacije: Vaganje,brojanje komada, postotno vaganje,kontrolno vaganje, dinamičko (animalno), vaganje,određivanje gustoće, akumulacijsko vaganje,formulacije. Velika baza podataka može sadržavati do 99 recepata uključujući 20 koraka (sastojaka) za svaki recept. 3 godine jamstvo.

ABL 125 42 g / 120 g 0,025 / 0,15 mg 0,05 / 0,2
Šifra
F81013 P100M 5-100 µl DF100ST, D200
F81022 P10M 0,5-10 µl D10, DL10, DF10ST, DFL10ST
F81017 M10ML 1-10 ml / repetativno 200 µl - 10 ml D10ML
F81015 M1200 100-1200 µl/ repetativno 20 µl - 1200 µl D1000, D1200, DF1000ST, DF1200ST
F81024 P200M 20-200 µl / repetativno 5 µl - 200 µl D200, D300, DF200ST, DF300ST
F81023 P20M 2-20 µl D200, DF30ST
F81014 P300M 20-300 µl / repetativno 10 - 300 µl D200, D300, DF200ST, DF300ST
F81016 M5000 500-5000 µl / repetativno 100 - 5000 µ D5000
CRP NycoCard Reader II
Šifra

NycoCard CRP test je dvominutni »Point of care« (POC) test (test koji se obavlja na mjestu gdje se bolesniku pruža skrb) kojim se utvrđuje je li infekcija bakterijska ili virusna. Mjeri se C-reaktivni protein (CRP), jedan od proteina akutne faze upale koji naglo raste kada dođe do infekcije. Količina uzorka: 5 µL. Tip uzorka: puna krv, serum ili plazma . Raspon mjerenja: 8 - 200 mg/l za uzorke pune krvi i 5 – 120 mg/l za uzorke seruma ili plazme.
1116807 | Test CRP (48 kom)
1116813 | HbA1c (24 kom)
1116811 | D-Dimer (24 kom)
1116819 | U-Albumin (24 kom)
Koagulometar COAG s INR
Šifra
03.3.5503.00
03.3.5505.00
Sustav za određivanje vrijednosti INR-a iz kapilarne pune krvi bez antikoagulansa ili venske pune krvi te plazme uz dodatak citratnog antikoagulansa, preporučuje se za kontrolu oralne antikoagulacijske terapije. Preporučuje se za kontrolu oralne antikoagulacijske terapije. Prijenosan, kompaktan i jednostavan za korištenje. Uz uređaj je uključeno 25 testova.

03.3.5505.00 | Test za Coag S INR (25 kom)
Analizator testnih trakica iz urina Contec BC401
Šifra
03.3.5760.00
03.1.5680.00
Visokoprecizni uređaj za očitavanje i analizu testnih trakica iz urina. Koristi se za utvrđivanje: GLU, BIL, SG, KET, BLD, PRO, URO, NIT, LEU, VC, PH, MAL, CR i UCA. Zaslon: 2,4’’ LCD u boji, visoke svjetline. Brzina rada: 50 testova / sat. Memorija: 500 rezultata. Pristupačno korisničko sučelje. Mikro USB, Bluetooth. Napajanje: ugrađena punjiva litijska baterija. Dimenzije: 13 x 7,3 x 3 cm. Težina: 0,18 kg.
03.1.5680.00 | Cybow 11M test trake, 100 kom
Laboratorijski uređaj Easy Reader+
Šifra
03.3.5762.00
03.3.5592.00
03.3.5504.00
03.1.5525.00
03.1.5562.00
Inovativni čitač rezultata brzih testova imunografskom metodom čiji integrirani softver analizira slike snimljene CCD kamerom visoke rezolucije. Rezultati su gotovi u manje od 15 minuta. Memorija: 1.000 rezultata sa slikama. Ugrađeni printer i zaslon osjetljiv na dodir. Rezultate je moguće dobiti iz uzoraka pune krvi, plazme, seruma i urina. Povezivanje: USB A, USB B, Ethernet, RS232, PS2, infrared. Testne trake (20 kom/pak)
03.3.5592.00 | CEA
03.3.5504.00 | CRP Check 1 Quick
03.1.5525.00 | PSA
03.1.5562.00 | CRP - FOB Check 2


Šifra
03.3.5747.00

Očitavanje i analiza testnih trakica iz urina. Zaslon: 4,3” LCD osjetljiv na dodir. Memorija: mogućnost pohrane 2000 rezultata. Brzina rada: 45 testova/sat (maksimalno 120 testova/sat). Komunikacijski port: USB. Napajanje: 12 V DC adapter ili 8 baterija od 1.5 V. Dim.: 188 × 74 × 77 mm. Težina: 430 g. Opcija: korisniku je dostupan i program (PC softver).
Testne trake:
03.1.4392.00, 03.1.4393.00, 03.1.4394.00, 03.1.4395.00, 03.1.4396.00, 03.1.4398.00, 03.1.0133.00, 03.1.0134.00, 03.1.1094.00

Glukometar Wellmed GU (glukoza,mokraćna kiselina)

Uređaj za mjerenje glukoze i mokraćne kiseline u krvi s velikim LCD zaslonom koji automatski identificira testne trakice; raspon mjerenja: glukoza: 20 do 600 mg/dL (1,1 do 33,3 mmol/l), mokraćna kiselina: 3 do 20 mg/dl (179 do 1190 mmol/l). Kapacitet memorije: pohrana 200 rezultata za glukozu i 100 rezultata za mokraćnu kiselinu. Vrijeme mjerenja: 10 s za glukozu i 20 s za mokraćnu kiselinu; uzorak: 4μl. Dodatna oprema: lancetar s 20 lanceta, kodna trakica, dvije baterije, torbica za uređaj, dnevnik mjerenja, jedan utor za trakicu jednostavan za uporabu, 10 trakica za mjerenje glukoze, 10 trakica za mjerenje mokraćne kiseline.
Glukometar Wellmed GCU (glukoza, kolesterol, mokraćna kiselina)

Uređaj za mjerenje glukoze, kolesterola i mokraćne kiseline u krvi s LCD zaslonom koji automatski identificira testne trakice. Vrijeme mjerenja: glukoza 10 s, kolesterol 150 s (iz 15 μl krvi), mokraćna kiselina 20 s (iz 4μl krvi). Memorija: pohrana 200 rezultata za glukozu, 50 za mokraćnukiselinu, 50 za kolesterol. Raspon mjerenja: glukoza: 20 do 600 mg/dl (1,1 do 33,3 mmol/l). Mokraćna kiselina: 3 do 20 mg/dl (179 do 1190 mmol/l), kolesterol: 100-400 mg/dl (2,6-10,4 mmol/l). Prosječne vrijednosti rezultata mjerenja glukoze po danima: 7, 14, 28 dana. Automatsko uključivanje i isključivanje. Dodatna oprema: lancetar, 20 lanceta, 2 baterije, torbica za uređaj, 10 trakica za mjerenje glukoze, 10 trakica za mjerenje mokraćne kiseline i 2 trakice za mjerenje kolesterola.
Trakice za mjerenje
šećera u krvi (glukoza) za Wellmed uređaje,
25 komada u pakiranju

Trakice za mjerenje mokraćne kiseline za Wellmed Easy Touch GCU i GU
Glukometar Wellmed GC (glukoza, kolesterol)

Uređaj za mjerenje glukoze i kolesterola iz uzorka krvi s velikim LCD zaslonom koji automatski identificira testne trakice; raspon mjerenja: glukoza: 20 do 600 mg /dL (1,1 do 33,3 mmol/l), kolesterol: 100 do 400 mg/dl (2,6 do 10,4 mmol/l). Volumen uzorka: 4μl /15μl. Vrijeme mjerenja: 10 s za glukozu i 20 s za kolesterol. Dimenzije: 88 × 64 × 22 mm. Prosječne vrijednosti rezultata mjerenja glukoze po danima: 7, 14, 28 dana. Automatsko uključivanje i isključivanje. Dodatna oprema: lancetar, 20 lanceta, kodna trakica, 2 baterije, torbica za uređaj, priručnik za uporabu, dnevnik mjerenja, 10 trakica za mjerenje glukoze i 2 trakice za mjerenje kolesterola.

Trakice za mjerenje kolesterola za Wellmed Easy Touch GC, GCHb i GCU
Trakice za mjerenje hemoglobina za Wellmed Easy Touch GCHb
25 komada u

10 komada u pakiranju

Trakice za mjerenje šećera u krvi (glukoza) za glukometar Wellmed Easy Touch Simple
25 komada u pakiranju

25 komada u pakiranju

Lancete za Wellmed GU, GCU i GC glukometre

Posudice za uzimanje uzoraka urina
Šifra 25035 FL-25185
Posudice za uzorak urina, pakirane pojedinačno u polipropilenske vrećice s poklopcem koji se zavrće i prostorom za upis podataka, sterilne, 120 ml
• PAKIRANJE - 1 kom

Posudice za uzimanje uzoraka stolice
Šifra 25165
Posudice za uzorak stolice, pakirane pojedinačno u polipropilenske vrećice; s crvenim poklopcem koji se zavrće i prostorom za upis podataka, sterilne, 60 ml
• PAKIRANJE - 1 kom

ZA UPITE VEZANO UZ RAZNI LABORATORIJSKI POTROŠNI MATERIJAL, MOLIMO VAS JAVITE SE PRODAJNOM PREDSTAVNIKU


Jednokratne epruvete


Pipete i nastavci za pipete




Posudice za uzorke za mikrobiologiju




Pokrovna stakalca
Šifra
03.4.2224.00
03.4.2608.00
03.4.1759.00
03.4.3736.00
03.4.2565.00

03.4.2224.00 | 18×18mm | 200 kom
03.4.2608.00 | 22x22mm | 200 kom
03.4.1759.00 | 24×32 mm | 100 kom
03.4.3736.00 | 24×50 mm | 100 kom
03.4.2565.00 | 24×60 mm | 100 kom
Predmetna stakalca za mikroskop Superfrost | 50 kom
Šifra
03.4.5664.04
03.4.5664.04 | narančasta

Drvena hvataljka za epruvete
Predmetna stakalca za mikroskop | 50 kom
Šifra
03.4.0910.00
03.4.2575.00
03.4.5362.00
03.4.0864.00
03.4.1646.00

03.4.0910.00 | Rezani rubovi
03.4.2575.00 | Superfrost, bijelo
03.4.5362.00 | Superfrost Extra bijelo
Kutijice za mikr. stakalca
03.4.0864.00 | za 50 kom
03.4.1646.00 | za 5 kom
Tarionici i tucala za tarionike
Šifra
03.4.1876.00
03.4.1877.00
03.4.2239.00
03.4.1874.00
03.4.1879.00
03.4.2240.00
Tarionici:
03.4.1876.00 | Ø 6 cm
03.4.1877.00 | Ø 10 cm
03.4.2239.00 | Ø 18 cm

Tucala za tarionike promjera:
03.4.1874.00 | Ø 6 cm
03.4.1879.00 | Ø 10 cm
03.4.2240.00 | Ø 18 cm

03.4.2070.00
Plastična mjerna posuda | Stakleno postolje
Šifra
03.4.1892.00 Šifra
03.4.1892.00 | 500 ml

12.0.1584.00
12.0.1584.00 | Stakleni
Špiritni plamenik | Stakleno postolje Menzure
03.4.1478.00
03.4.0637.00


03.4.1478.00 |
Mjeri specifičnu gustoću urina.

Staklena mjerna posuda
Šifra
03.4.2380.00
03.4.2381.00
03.4.1507.00
03.4.2382.00
03.4.2273.00
03.4.1505.00
03.4.1504.00
03.4.2406.00

03.4.2380.00 | 50 ml
03.4.2381.00 | 100 ml
03.4.1507.00 | 250 ml
03.4.2382.00 | 400 ml
03.4.2273.00 | 600 ml
03.4.1505.00 | 800 ml
03.4.1504.00 | 1000 ml
03.4.2406.00 | 2000 ml
Stalci za epruvete
Šifra
03.4.1885.00
03.4.2580.00
03.4.0848.00
Stalak za epruvete | Žičani
03.4.1885.00 | 30 epruveta
Stalak za epruvete | Plastični
03.4.2580.00 | 24 epruvete | fi 30 mm
03.4.0848.00 | 60 epruveta | fi 16 mm

Alkohol tester Momert MM1707
Šifra MM1707
Idealan za svakog vozača. Malen i lagan, stane u svaki pretinac unutar automobila ili motora. Momert MM1707 alkotester idealan je i za kućnu upotrebu - za ljutu suprugu, za veselog muža ili neshvaćene tinejdžere. Raspon mjerenja: 0 do 2,00 ‰ (1,00 mg/L). Precizno mjerenje alkohola u krvi: +/- 0,15 ‰ na 0,50 ‰. Vrlo jednostavan za upotrebu - ne zahtjeva korištenje usnika. Automatsko isključivanje. Napajanje: 2 × AAA baterije. Dimenzije: 4,2 cm (Š) x 10 cm (V) x 16 cm (D).

Dräger Alcotest® 6000
D413706961
Dräger Alcotest® 6000 profesionalnom korisniku omogućuje brzinu i preciznost provođenja ispitivanja prisutnosti alkohola u dahu ispitanika. Osim aktivnog mjerenja pristurnosti alkohola na samom ispitaniku, ovaj uređaj omogućava i pasivni način mjerenja prisutnosti alkohola u zraku (tada nije potrebno koristiti usnik). Analiza je pouzdana čak i na temperaturama od -5 do +50 ° C. Veliki zaslon s pozadinskim osvjetljenjem, lako razumljive poruke koje intuitivno vode korisnika kroz sučelje, LED I zvučni signali koji korisnika obaviještavaju o provedenom testiranju, jednostavno postavljanje usnika čak i u mraku čine rad ovim analizatorom jednostavnim i brzim. Posebno osmišljen otvor za zrak onemogućava svaku opstrukciju i manipulaciju analizatorom kod provedbe testiranja. Analizator je opremljen razmaknikom koji sprječava njegov izravan kontakt s usama te se može koristiti za izbacivanje usnika. Usnici s povratnim ventilom su dostupni na zahtjev.

Digitalni alkohol tester CA-8005
CA-8005 C421000023

Digitalni alkohol tester CA-8005 predviđen je za mjerenje koncentracije alkohola u dahu. Trajanje mjerenja pri upuhivanju: 6 sekundi. Protok zraka pri upuhivanju: 10l/ min. Preciznost mjerenja: +/-0.05 ‰ BAC na 0.50 ‰ BAC. Napajanje: 9V baterija. Funkcija automatskog isključivanja: Uređaj se gasi nakon 1 minute. Mjere: 125 x 67 x 28 mm.
C421000023 | Rezervni usnik za alkohol testere CA- 010/2020/8005 | 25 komada/pakiranje

Dräger Alcotest® 7000

Dräger Alcotest® 7000 postavlja nove standarde za uređaje za provjeru prisutnosti alkohola. Njegove su prednosti širi temperaturni i mjerni raspon, nezahtjevno održavanje i razne mogućnosti umrežavanja. Pored toga, uređaj može vršiti alkotest putem usnika i lijevka. Pouzdani alkotestovi nikad nisu bili brži, jednostavniji i učinkovitiji. Pored klasičnog testiranja pomoću usnika, uređajem Alcotest 7000 testiranje možete obaviti i pomoću nastavka u obliku lijevka. To omogućuje obavljanje velikog broja alkotestova u vrlo kratkom vremenskom roku: štedi vrijeme, novac i higijenski je. Test pomoću lijevka pruža vam početnu naznaku je li alkohol prisutan u dahu ispitanika. Ako je odgovor pozitivan, jednostavno pritisnite gumb za prebacivanje u način testiranja pomoću usnika. Naredni test potom će vam pokazati stvarnu razinu alkohola u dahu ispitanika. Uređajem Alcotest 7000 pouzdana se mjerenja mogu obaviti čak i pri ekstremnim temperaturama.
Surecheck test za trudnoću


Točnost testa je 99% od prvog dana izostanka menstruacije. Surecheck® test za trudnoću registrira prisutnost hCG hormona u mokraći, u kojoj se pojavljuje vrlo brzo nakon začeća. Brzi test i jednostavan za upotrebu, dovoljno ga je postaviti pod urinarni mlaz 5 sekundi. Dostupna besplatna aplikacija Surecheck kalendar za Andorid i IOS operativni sustav. 1 komad u pakovanju.
Oview 5 ovulacijski test

Oview® je pouzdan i jednostavan test za utvrđivanje najplodnijih dana za začeće - kada postoji najveća vjerojatnost ovulacije. Oview® predviđa razdoblje ovulacije, registriranjem specifičnog hormona u urinu – luteinizirajućeg hormona. (LH). Visoka preciznost od preko 99%. Paket sadrži set od 5 test traka.
THC Tetrahidrokanabiol Aktivna psihoaktivna tvar, pronađena u biljci konoplje i hašišu. / Trava, vutra, marica, žiža
COC Kokain
OPI
Opijati
AMP Amfetamin
MET Metamfetamin
Psihostimulans dobiven preradom biljke koke. / Koka, bijelo, dama
Heroin, morfin i kodein* (*lijek za ublažavanje bolova i kašlja). /Hors (heroin)
Sintetička droga koja stimulativno djeluje na živčani sistem. / Speed, base
Psihostimulans iz skupine amfetamina. / Meth, ice, leda
BZO Benzodiazepin Lijekovi za smirenje (trankvilizanti, sedativi, anksiolitici, sredstva za spavanje i hipnotici). /Librium, Vitamin V
OXY Oksikodon
MDMA 3,4-metilenedioksi-metamfetamin
PCP Feniciklidin
BUP Buprenorfin
BAR Barbiturati
TCA Triciklički antidepresivi
MTD Metadon
EDDP Metaboliti metadona
MOP Metaboliti opijata
Opiodni analgetik.
Sintetička psihoaktivna droga. / Ecstasy, Ex, mrma, Molly
Halucinogen s anestetičkim djelovanjem. / Anđeoska prašina, angeldust, superduvan
Semi-sintetski opioid (lijek za heroinske ovisnike).
Lijekovi za spavanje i smirenje. / Nembutal, Seconal
Amyzol, tryptyhol, Prazine, tofranil, Anafranil, Ladiomil.
Sintetički opijat s dugotrajnim djelovanjem. / Meta
Metaboliti dobiveni procesiranjem metadona kroz tijelo.
Metaboliti dobiveni procesiranjem heroina, morfina i kodeina kroz tijelo.
Brz i pouzdan individualno zapakiran test za otkrivanje 5 najčešće konzumiranih droga. Ovaj multi-dip test opremljen je higijenskom kapicom koja se može ponovno staviti nakon uzimanja uzorka čime se smanjuje rizik od kontaminacije. Vizualne upute za uporabu pričvršćene su izravno na kućište testa radi sigurne primjene. Test je potrebno čuvati na temperaturi od 2 do 30 °C. Pakiranje 25 komada.
UPUTE ZA UPORABU
Test trakice i uzorak urina treba staviti na sobnu temperaturu (15°C-30°C) prije testiranja.
1) Izvadite test trakice iz folijske vrećice.
Skinite zaštitnu kapicu s test trakica.
2) Uronite test trakice u uzorak urina na 15-30 sekundi. Urin u koji uranjate trakice ne smije prijeći oznaku MAX.
Odložite na ravnu nepropusnu čistu površinu.
3) Nakon 5-8 minuta pročitajte rezultate.
Nemojte čitati rezultate nakon više od 8 minuta.
Test trakice za otkrivanje 5 vrsta droga u urinu


Test trakice za otkrivanje 10 vrsta droga u urinu

Test trakice za otkrivanje 12 vrsta droga u urinu
Test otkriva:
• amfetamin (AMP) 1000 ng/mL
• kokain (COC) 300 ng/mL
• metamfetamin (MET) 1000 ng/mL
• morfin/opijati (MOR/OPI) 300 ng/mL
• kanabinoidi (THC) 50 ng/mL
Test otkriva:
• amfetamin (AMP) 1000 ng/mL
• barbiturate (BAR) 300 ng/mL
• benzodiazepin (BZD) 300 ng/mL
• kokain (COC) 300 ng/mL
• ecstasy (MDMA) 500 ng/mL
• metamfetamin (MET) 1000 ng/mL
• morfin/opijati (MOR/OPI) 300 ng/mL
• metadon (MTD) 300 ng/mL
• triciklički antidepresivi (TCA) 1000 ng/mL
• kanabinoidi (THC) 50 ng/mL
Test otkriva:
• amfetamin (AMP) 1000 ng/mL
• barbiturate (BAR) 300 ng/mL
• buprenorfin (BUP) 10 ng/mL
• benzodiazepin (BZD) 300 ng/mL
• kokain (COC) 300 ng/mL
• EDDP 100 ng/mL
• ecstasy (MDMA) 500 ng/mL
• metamfetamin (MET) 1000 ng/mL
• morfin/opijati (MOR/OPI) 300 ng/mL
• metadon (MTD) 300 ng/mL
• triciklički antidepresivi (TCA) 1000 ng/mL
• kanabinoidi (THC) 50 ng/mL



Šifra Opis
001 401 150 cm | plavi | 200 kom
001 402 150 cm | plavi | 180 kom
Dijelovi seta za infuziju IS:
• Poklopac za šiljak sa uzdužnim rebrima za jednostavno uklanjanje

• Dvokanalni šiljak za sprječavanje ispadanja seta iz spremnika i istjecanja tekućine iz priključka, jednostavno umetanje čak i za male mekane spremnike
• Cijev za kapanje 20 kapi = 1 ml ± 0,1 ml
• Luer-lock konektor s poklopcem
• 150 cm duge cijevi bez DEHP, BBP, DBP
• Hidrofobni filter zraka
• Duga komora bez PVC-a, prozirna, od savitljive plastike; omogućuje jednostavno određivanje razine tekućine; mekana i ugodana za korištenje
• Filter za tekućinu od 15 μm
• Poklopac za uključivanje/isključivanje hidrofobnog filtra za zrak u plavoj boji
• Rola regulatora protoka daje mogućnost preciznog doziranja ili zaustavljanja tekućine
• Regulator protoka, podesiv min. 15 mm
• Mjesto za odlaganje šiljka nakon uporabe
Šifra Opis
001 751 150 cm | plavi | 200 kom
001 753 150 cm | plavi | 150 kom
Dijelovi seta za infuziju IS PRO:
• Poklopac za šiljak sa uzdužnim rebrima za jednostavno uklanjanje
• Dvokanalni šiljak, sprječava ispadanje infuzijskog seta iz spremnika i istjecanje tekućine iz priključka te smanjuje vrijeme pražnjenja spremnika s tekućinom
• Cijev za kapanje 20 kapi = 1 ml ± 0,1 mlz
• Luer-lock konektor s poklopcem
• 150 cm duge cijevi bez DEHP, BBP, DBP
• Hidrofobni filtar zraka

• Dugačka komora za kapanje bez PVC-a, prozirna, izrađena od fleksibilne plastike omogućuje jednostavno određivanje razine tekućine i jednostavno praćenje brzine kapanja, mekana i udobna za korištenje
• Filter za tekućinu od 15 μm
• Poklopac za uključivanje/isključivanje hidrofobnog filtra za zrak u plavoj boji
Opcija: Set za infuziju osjetljivih tekućina na svjetlost: Jantarna boja štiti tekućine osjetljive na svjetlost i blokira 90% UV zraka valne duljine od 290 do 450 nm.
Šifra Opis
001 409 150 cm | plavi | 200 kom

Šifra Opis
• Mjesto za odlaganje inf.cijevi Komponente štrcaljke za infuzijske pumpe:
007 111 50 (60) ml | prozirna | 85 kom
007 121 50 (60) ml | jantarna | 85 kom
• Luer lock konektor
• Brtve od termoplastičnog elastomera
• Dvostrana, čitljiva, neizbrisiva mjerna ljestvica za lakše odmjeravanje količine lijeka
• Cijev štrcaljke s otvorom za sprječavanje ispadanja klipa
• Klip šprice
Opcija: Štrcaljka za otopine osjetljive na svjetlost: Jantarna boja štiti tekućine osjetljive na svjetlost i blokira 90% UV zraka valne duljine od 290 do 450 nm.


• Rola regulatora protoka daje mogućnost preciznog doziranja ili zaustavljanja tekućine
• Regulator protoka, podesiv, min. 15 mm
• Mjesto za odlaganje šiljka nakon uporabe
• Mjesto za odlaganje inf. cijevi
– tipTS
Šifra Opis
002 301 150 cm | crveni | 180 kom
002 430 220 cm | crveni | 150 kom
Transfuzijski set za gravitacijsku transfuziju krvi ili krvnih sastojaka. Transfuzijski setovi tipa TS su proizvodi samo za jednokratnu upotrebu, apirogeni, netoksični, sterilizirani etilen oksidom. Setovi ne sadrže lateks.
Dijelovi seta za infuziju TS:

• Poklopac za šiljke s uzdužnim rebrima za jednostavno uklanjanje
• Dvokanalni šiljak za sprječavanje ispadanja kompleta iz spremnika i istjecanja tekućine iz priključka, jednostavno umetanje čak iu male mekane spremnike
• Cijev za kapanje 20 kapi = 1 ml ± 0,1 ml
• Luer-lock konektor s poklopcem
• 150 cm duge cijevi DEHP, BBP, DBP besplatno
• Hidrofobni filtar zraka
• Dugačka komora za kapanje bez PVC-a, prozirna, izrađena od fleksibilne plastike omogućuje jednostavno određivanje razine tekućine i jednostavno praćenje brzine kapanja, mekana i udobna za korištenje
• Filtar za krv s veličinom oka 200 μm
• Poklopac za uključivanje/isključivanje filtera za zrak u crvenoj boji
• Regulator protoka daje mogućnost preciznog doziranja ili zaustavljanja protoka tekućine
• Mjesto za šiljak nakon upotrebe
• Mjesto za odlaganje inf. cijevi
Šprice sa kateterskim nastavkom (produžena mjerna skala)

Dvodjelne šprice, luer
PAKIRANJE -
2
5
Dvodjelne šprice LUXINJECT
Produžena mjerna skala – mogućnost korištenja manje štrcaljke za međivolemene:
Trodjelne šprice, luer
PAKIRANJE - 100 KOMADA

Šifra Opis
010 020 2 ml | prozirna | 30x100 kom
010 050 5 ml | prozirna | 20x100 kom
010 100 10 ml | prozirna | 12x100 kom
010 200 20 ml | prozirna | 8x100 kom
Trodjelne šprice, luer lock
3
5




Trodijelna šprica za enteralnu prehranu, EnFit


Tuberkulinske šprice, luer lock
PAKIRANJE - 100 KOMADA

KDM-831915
KDM-831922 10
KDM-831939 20
KDM-831946 30


Inzulinske šprice
PAKIRANJE - 100 KOMADA

PAKIRANJE -
2,1 x 40 14
1,8 x 40 15
1,6 x 40 16
1,6 x 40 16
1,2 x 40 18
1,2 x 50 18
1,1 x 40 19
1,10 x 50 19
0,9 x 25 20
0,9 x 40 20
0,9 x 40 20
0,9 x 50 20
0,9 x 70 20
0,8 x 16 21
0,8 x 22 21
0,8 x 25 21
0,8 x 40 21
0,8 x 50 21
0,7 x 30 22
0,7 x 40 22
0,7 x 50 22
0,70 x 50 22
0,6 x 25 23
0,6 x 25 23
0,6 x 30 23
0,6 x 30 23
0,6 x 40 23
0,5 x 16 25
0,55 x 25 25
0,5 x 25 25
0,5 x 25 25
0,45 x 13 26
0,45 x 16 26
0,45 x 16 26
0,45 x 25 26
0,33 x 12 29
0,3 x 13 30
KDM-900390
KDM-900413
KDM-900437
KDM-B948982
KDM-900062
KDM-B949019
KDM-900109
KDM-B949088
KDM-900123
KDM-900130
KDM-B949101
KDM-900482
KDM-900499
KDM-900505
KDM-900512
KDM-900529
KDM-900192
KDM-900536
KDM-900581
KDM-900260
KDM-900598
KDM-B949255
KDM-900284_100
KDM-B949262
KDM-900291
KDM-B949279
KDM-900604
KDM-900345
KDM-900635
KDM-900642
KDM-B949347
KDM-908327
KDM-900673
KDM-D949392
KDM-900697
KDM-900741
KDM-B949026

0,50 x 88 25
0,50 x 88 25
0,45 x 88 26
0,45 x 88 26
0,40 x 88 27

KDM-901175
KDM-901144
KDM-901182
KDM-901151
KDM-901441

PAKIRANJE -
1,30 x 75 18
1,20 x 88 18
1,10 x 88 19
0,90 x 75 20
0,90 x 88 20
0,90 x 90 20
0,80 x 88 21
0,70 x 40 22
0,70 x 75 22
0,70 x 88 22
0,70 x 90 22
0,60 x 88 23
0,55 x 88 24
0,50 x 88 25
0,45 x 88 26
0,40 x 88 27
KDM-900840
KDM-900857
KDM-900864
KDM-900888
KDM-900895
KDM-901199
KDM-901069
KDM-900918
KDM-901021
KDM-900901
KDM-901212
KDM-901083
KDM-901045
KDM-900925
KDM-901106
KDM-901120
Dim (mm) Vel (G) Šifra
1,20 x 19 18 KDM-741801D
1,10 x 19 19 KDM-741900D
0,90 x 19 20 KDM-742006D
0,80 x 19 21 KDM-742105D
0,70 x 19 22
0,60 x 19 23
0,50 x 19 25
KDM-742204D
KDM-742303D
KDM-742501D



INTRAVENSKE KANILE KD FIX (sa krilcima i dodatnim portom)

PAKIRANJE - 50 KOMADA
Dim (mm) Vel (G) Boja Šifra
2,1 x 45 14
1,7 x 45 16
1,5 x 45 17
1,3 x 45 18
1,1 x 32 20
0,9 x 25 22
0,7 x 19 24
0,62 x 19 26
KDM-762141M
KDM-762165M
KDM-762172M
KDM-762189M
KDM-762202M
KDM-762226M
KDM-762240M
KDM-766125M
INTRAVENSKE KANILE KD FIX MONO (sa krilcima, bez dodatnog porta)
PAKIRANJE - 50 KOMADA
Dim (mm) Vel (G) Boja Šifra
2,1 x 45 14
1,7 x 45 16
1,5 x 45 17
1,3 x 45 18
1,1 x 32 20
0,9 x 25 22
0,7 x 19 24
0,62 x 19 26
KDM-766378M
KDM-766385M
KDM-766392M
KDM-766408M
KDM-766415M
KDM-766422M
KDM-766439M
KDM-766446M
INTRAVENSKE KANILE KD FIX
SAFETY PUR (sa sigurnosnim mehanizmom protiv uboda, sa krilcima, sa dodatnim portom, sa filterom)
PAKIRANJE - 50 KOMADA
Dim (mm) Vel (G) Boja Šifra
2,1 x 45 14
1,7 x 45 16
1,5 x 45 17
1,3 x 45 18
1,1 x 32 20
0,9 x 25 22
0,7 x 19 24

SINGFILLER | hijaluronski fileri
1 | nazolabijalne bore
2 | bore mrštilice
3 | bore na čelu
4 | vrat
5 | nos
6 | brada
7 | usne
8 | uške
9 | bore na čelu
10 | obrazi
Singfiller hijaluronski fileri poznati su po dugotrajnim estetskim rezultatima i lakoći primjene. Ovisno o tipu kože i sastavu tijela pojedinca, rezultati obično traju 6-12 mjeseci. Primjenu proizvoda, sa ili bez lidokaina, smiju obavljati isključivo educirani i medicinski kvalificirani stručnjaci, uključujući osobe iz zdravstvenih i medicinskih djelatnosti. Singfiller FINE V1

Prednapunjena hijaluronska štrcaljka Singfiller FINE V1 ima najnižu razinu viskoznosti u seriji te se može primijeniti na cijelom licu. Ovo je idealan proizvod za početak korištenja filera jer se brzo apsorbira u tijelu i lako injektira. Hijaluronska štrcaljka Singfiller FINE V1 sadrži 1 ml umrežene hijaluronske kiseline.
Singfiller DEEP V3
KDM-767177
KDM-767184
KDM-767191
KDM-767207
KDM-767214
KDM-767221
KDM-767238

Prednapunjena hijaluronska štrcaljka Singfiller DEEP V3 ima drugu najvišu razinu viskoznosti u seriji. Kupci često biraju ovu razinu viskoznosti kada žele dugotrajne rezultate, a pritom zadržati prirodan izgled. Zahvaljujući iglama veličine 27G i priloženim iglama veličine 26G, injektiranje je jednostavno čak i s povećanom viskoznošću.
Singfiller DERM V2

Singfiller DERM V2 hijaluronska štrcaljka prikladna je za sve namjene. Prednapunjena štrcaljka od 1 ml omogućuje iznimno jednostavnu primjenu, a ultra tanka igla veličine 30G osigurava nježno injektiranje i gotovo bezbolan tretman. Za lakšu primjenu možete koristiti i priloženu nešto deblju iglu veličine 27G.
Singfiller DEEPER V4

Premium medicinski proizvod za sigurno injektiranje i popunjavanje dubljih bora | za izraženiji izgled. Prednapunjena hijaluronska štrcaljka Singfiller DEEPER V4 ima najvišu razinu viskoznosti u seriji. Dolazi u steriliziranoj jednokratnoj štrcaljki od 1 ml, spremnoj za trenutnu primjenu. Sadrži 20 mg/ml visoko koncentrirane umrežene hijaluronske kiseline.
Sterilne posudice za uzimanje uzoraka urina
Pakirane pojedinačno u polipropilenske vrećice s poklopcem koji se zavrće i prostorom za upis podataka, sterilne Pakiranje: 1 komad.
Šifra
FL-25175


Sterilne posudice za uzimanje uzoraka stolice
Pakirane pojedinačno u polipropilenske vrećice s crvenim poklopcem koji se zavrće i prostorom za upis podataka, sterilne Pakiranje: 1 komad.


Petrijeve zdjelice, pakiranje - 20 komada
Šifra Opis
FL-29042 ø 90 mm, 14,2 mm (V) | nesterilne
FL-29052 ø 90 mm, 16,2 mm (V) | nesterilne
FL-29082 ø 90 mm, 14,2 mm (V) | sterilne
FL-29062 ø 90 mm, 16,2 mm (V) | sterilne
FL-29040 ø 60 mm, 14,2 mm (V) | nesterilne
Inokulacijske petlje, polistiren, tvrde, pakiranje - 1000 komada
Šifra Opis
FL-30010 1 μl | zelene
FL-30020 10 μl | plave
Pipete, pakiranje - 1000 kom
FL-29050 ø 60 mm, 14,2 mm (V) | sterilne Šifra Opis

24-satni spremnik za skupljanje urina s ergonomskom ručkom , 3000ml, polietilen, pakiranje - 1 komad



FL-28052 0 -200 μl | žuta | tip Eppendorf - Brand - Socorex
FL-28053 100 -1000 μl| plava | tip Eppendorf - Brand - Socorex
FL-28063 0 -200 μl | žuta | tip Gilson
Nastavci za pipete, pakiranje - 500 komada
1ml
3ml


Štapići za briseve s vrhom od vate
drveni | 500 kom pak.
plastični | 100 kom pak.


Plastični štapić za bris polipropilenskoj epruveti 12×150 mm, pakiranje - 100 komada
ø 90 mm, 14,2 mm (V) | sterilne

Pipete na stalku, tip




Sterilni nastavci za pipete, pakiranje - 1000 komada
Opis

Eppendorf - Brand - Socorex pakiranje - 96 komada


Jednokratne epruvete | Promed
Polistirenske, bez ruba, 5 ml, pakiranje - 250 komada
Šifra Opis
FL-21054 12x75mm
FL-21050 13x75mm
Polipropilenske mikro epruvete, pakiranje500 komada


Šifra Opis
FL-23053 1,5ml
FL-23073 2ml
Bez ruba, 10 ml, 16x100mm, pakiranje - 2000 komada
Šifra Opis
FL-21021 polipropilen
FL-21075 polistiren


Konusne epruvete za centrifugu, polipropilenske, pakiranje - 100 komada
Šifra Opis
FL-21401 plavi čep | nesterilna | 50 ml - 30x115 mm
FL-21402 crveni čep | sterilna | 50 ml - 30x115 mm
FL-21408 plavi čep | nesterilna | 15 ml - 17x120 mm
FL-21409 crveni čep | sterilna | 15 ml - 17x120 mm
Jednokratne igle za vacutainer epruvete | Vacumed
Tech sterilna igla
Šifra Opis
FL-45404 21Gx1 1/2 zelena | 100 kom

Poklopci za epruvete, polietilen, 1000 kom/pakiranje | Promed
Šifra Opis
FL-21341 Ø 12 mm | neutral
FL-21351 Ø 13 mm | neutral
FL-21361 Ø 16 mm | neutral
Zaštitni držač epruvete za vađenje krvi







Tech sterilni set za vađenje krvi, cijevi dužine 178 mm
Šifra Opis
FL-45501 21G x 3/4 zeleni | 50 kom
FL-45503 21G x 3/4 plavi | 50 kom
FL-45701 23G x 3/4 zeleni | 50 kom
FL-45703 23G x 3/4 plavi | 50 kom


Četkice za uzimanje citološkog uzorka, sterilne, pakiranje - 100 komada
10.0.0189.00 Šifra Opis
10.0.0123.00 Brush
10.0.3490.00 Cell-Brush


Kirurška pamučna traka
Šifra Opis
5m x 2,5cm
5m x 5cm
Izrađena je od obične pamučne tkanine s ljepilom koje sadrži cinkov oksid koji se dodaje da bi se osiguralo dugotrajno prianjanje i spriječila infekcija.


Tekstilni flaster za prvu pomoć

Idealan za posjekotine, ogrebotine i manje ozljede za koje je potrebna prva pomoć. Štiti rane od prašine i bakterija. 10 flastera, 19 x 72mm.

Vodootporni flasteri
Vodootporan flaster za zaštitu posjekotina, ogrebotina i manjih ozljeda od prljavštine i bakterija. 10 flastera, 19 x 72mm.
Netkani flaster


Većinom se koriste kao primarni zavoji za postoperativne rane sa šavovima, ogrebotine i manje posjekotine. Meki i udobni. 10 flastera, 5 x 7,5 cm
Netkana upijajuća kompresa

Idealna za zbrinjavanje, čišćenje i zaštitu rana. Napravljena od visokoupijajućeg netkanog tekstila. Visokoupijajuća i meka, EO sterilizacija / nesterilno. 5 paketa x 5 kompresa, 7,5 x 7,5 cm
Kirurška traka od umjetne svile
Šifra Opis
OC-11502 5m x 2,5cm
5m x 5cm
Izrađena je od umjetne svilene tkanine s ljepilom koje sadrži cinkov oksid koji se dodaje da bi se osiguralo dugotrajno prianjanje i spriječila infekcija.


Standardni flaster za prvu pomoć

Idealan za posjekotine, ogrebotine i manje ozljede za koje je potrebna prva pomoć. Štiti rane od prašine i bakterija. 20 flastera razne veličine.
Flaster za prvu pomoć za osjetljivu kožu

Izrađen od netkanog, mekog tekstila. Idealan za posjekotine, ogrebotine i manje ozljede za koje je potrebna prva pomoć. Dvije veličine: 19 x 72mm - 10 flastera; 25 x 72mm - 4 flastera.
Flaster za prvu pomoć u bojama

Idealan za posjekotine, ogrebotine i manje ozljede za koje je potrebna prva pomoć. Štiti rane od prašine i bakterija. 20 flastera, 19 x 72mm.
Dječji flaster za oko za dječake

Idealno štite oko za vrijeme liječenja različitih stanja kao što su ambliopija, strabizam, lijeno oko itd. Napravljeni od netkanog pamuka koji omogućava koži da diše. 50 komada u pakiranju.
Mikroporozna (papirnata) kirurška traka
Šifra Opis
OC-12502 5m x 2,5cm OC-12505 5m x 5cm
Izrađena je od netkanog tekstila i ima hipoalergensko ljepilo osmišljeno za jako prianjanje na kožu, zavoje i donje slojeve trake.


Kombinirani flaster za prvu pomoć
Šifra

Idealan za posjekotine, ogrebotine i manje ozljede za koje je potrebna prva pomoć. Sadrži razne najtraženije veličine. 20 flastera raznih veličina.
Flaster za prvu pomoć s Garfieldom
Šifra

Djeca obožavaju ove genijalne flastere s najpoznatijom mačkom na svijetu - Garfieldom. Vodootporan i otporan na prljanje, ne lijepi se za ranu, hipoalergenski. 12 flastera, 19 x 76mm
Flaster za prvu pomoć s likovima iz crtića
Vodootporan i otporan na nečistoću. Ne lijepi se za ranu, hipoalergenski 20 flastera razne veličine.

Dječji flaster za oko za djevojčice

Napravljeni od netkanog pamuka koji omogućava koži da diše. 20 komada u pakiranju. Posebna zaštitna pločica osigurava maksimalnu zaštitu od prodora svjetlosti.
Elastične netkane kirurške trake u roli
Šifra Opis
OC-15505 5m x 5cm
OC-15502 5m x 2,5cm
OC-15110 10m x 10cm
OC-15115 10m x 15cm
Izrađen od netkanog materijala. Koristi se za različite primjene poput osiguranja velikih zavoja, cijevčica poput katetera i IV kanila, za stabilizaciju udlaga prstiju i slično. Hipoalergenski - pogodan je za osjetljivu kožu. Propušta rendgenske zrake. Praktičan i jednostavan za stavljanje/skidanje.




Zavoj od pamučne gaze
Šifra Opis
OC-22105 10cmx50m 1 kom
OC-22160 15cmx10m 10 kom
Visoka sposobnost upijanja i mekoća na dodir. Izdržljiva, koristi se za imobilizaciju, pletenih rubova, nesterilna. Ne smije se koristiti na otvorenim ranama, pojedinačno pakirana.


Elastični zavoj od gaze
Šifra Opis
OC-2306 6 cm x 4 m
OC-2308 8 cm x 4 m
OC-2310 10 cm x 4 m
Sadrži 48% poliamida i 52% viskoze. Koristi se kao potporni zavoj u slučajevima koji zahtijevaju laganu kompresiju. Njegova porozna struktura omogućava koži i rani da dišu. Nesterilni, ne smije se koristiti na otvorenim ranama. 50 komada.
Micropore traka


Izrađena je od netkanog tekstila i ima hipoalergensko ljepilo osmišljeno za jako prianjanje na kožu, zavoje i donje slojeve trake, ali se istovremeno lako skida bez oštećenja kože. 9,14 m x 1,25 cm.
Sterilni flasteri za previjanje rana

Mogu se koristiti za zaštitu zašivenih rana nakon operacije i kod promjene obloga i zavoja. Propusan za rendgenske zrake. Izrađeni su od fleksibilnog netkanog materijala zahvaljujući čemu se prilagođavaju oblinama tijela. 50 flastera 5 cm x 7,5 cm.
Fllasteri za fiksiranje katetera i IV kanile

Flasteri su idealni za fiksaciju intravaskularnih uređaja poput katetera i kanila. Dostupni su s visoko upijajućim i neljepljivim jastučićem koji omogućuje brže zacjeljivanje rane. 50 flastera 6x9,5 cm.
Kohezivni zavoj
Šifra Opis
Pruža potporu, pouzdanu kompresiju i laganu toplinu slabim ili ozlijeđenim udovima i zglobovima. Samoljepljivi odnosno samoprijanjajući zavoj ne ljepi se na kožu. Lagan i izdržljiv.
Sterilna upijajuća gaza od netkanog materijala, 10x10cm | 150 komada
Šifra Opis
OC-2160 8 Ply (sterilna), 300 kom
OC-40104 4 Ply (nesterilna), 600 kom
OC-40108 8 Ply (nesterilna), 300 kom
Idealna za njegu, čišćenje i pokrivanje rana. Izrađena je od visoko upijajućeg netkanog materijala. Dolazi u pojedinačnom EO steriliziranom pakiranju ili u nesterilnom grupnom pakiranju (nesterilna varijanta dostupna je u 4 ili 8 slojeva). Propusna za X-zrake.

Prozirna poliuretanska obloga za rane - flaster
Šifra Opis
OC-21507 5 x 7,5cm
OC-21910 9 x 10 cm

Ova elastična prozirna obloga za rane - flaster napravljena je od poliuretanskog filma. Lako se prilagođava konturama tijela. Prikladna je za korištenje kao primarni zavoj. 50 komada, 5 x 7,5 cm.


Netkana, mikroporozna kirurška traka u roli
OC-43407 7,5 cm x 4,5 m OC-43410 10 cm x 4,5 m Šifra
3M-1530 A 12,5 mm x 14 m 3M-1530 B 25 mm x 9,14 m Šifra
Za upotrebu kod fiksiranja zavoja, tuba, sondi i kanila posebice kod djece i starijih osoba sa osjetljivom kožom. 3M Micropore nije sterilni proizvod. Može se sterilizirati.

Transparentna perforirana ljepljiva kirurška traka

Šifra Opis
3M-1527 B 25 mm x 9,14 m
3M Transpore transparentna perforirana ljepljiva kirurška traka hipoalergenski je proizvod koji omogućava postojano disanje kože i dobro prijanjanje.

Elastična ljepljiva zaštitna traka


Sastoji se od vrlo elastične, meke i prilagodljive potpore načinjenje od netkanih poliesterskih vlakana. Omogućava lako fiksiranje bilo kojeg tipa zavoja.

Ljepljiva traka od umjetne svile

Šifra Opis
3M-1538 B 12,5 mm x 14 m
Tekstilna kirurška traka od umjetne svile velike rastezljivosti i s visokom vrijednošću adhezije. Sastav od pletenih vlakana omogućava lako trganje bez upotreba škara .

Standardna oksigenirana regenerirana celuloza
Pletena resorbirajuća tkanina sačinjena od oksidirane regenerirane celuloze bijele do blijedo žute boje.
• Niski pH stvara baktericidnu okolinu
• Biljna osnova / podrijetlo
• Trajanje apsorpcije 7-14 dana
• Hemostaza unutar 2 minute

Bakteriostatsko i baktericidno djelovanje sa učinkom na gram pozitivne i gram negativne organizme uključujući aerobne i anaerobne bakterije uključujući PRSP,VRE,MRSE. Proizvod je pojedinačno pakiran u nepropusnu foliju, 12 kom /kut., različite veličine: od 1,2x5 cm (najmanja veličina) do 10x20 cm (najveća veličina).
Oksigenirana regenerirana celuloza visoke gustoće
Idealan izbor za jača krvarenja. Materijal visoke gustoće i čvrstoće mogućava omotavanje, šivanje i oblikovanje po potrebi. Ne ljepi se na rukavice i instrumente.

• Trauma, laparoskopska kirurgija, uporaba kod jačih krvarenja
• Brže zaustavljanje krvarenja u usporedbi sa Standardnim hemostatikom
• 3x gušći od Standarda
• Utječe na snižavanje PH Proizvod je pojedinačno pakiran u nepropusnu foliju, 10 ili 12 kom /kut., veličine: od 2,6x2,6 cm (najmanja veličina) do 15,2x22,9 cm (najveća veličina).
Hemostatik u prahu (biljni polisaharid)
Najnoviji resorbirajući lokalni hemostatik, koji je razvijen za kontrolu hemostaze kod upornog i dugotrajnog krvarenja na većim površinama. Čestice su biokompatibilne, apirogene, biljnog porijekla, proizvedene iz pročišćenog biljnog škroba.

Želatinske spužvice
Spužvice za brzu i učinkovitu intraoperativnu hemostazu. Hemostatik je apirogen, netoksičan, ne izaziva alergijsku reakciju. Potpuno se apsorbira unutar 3-4 tjedna, bez ostataka i kapsuliranja.

Oksigenirana regenerirana celuloza razdvojiva u slojevima
Sastoji se od više slojeva i može sa koristiti u pojedinačnim slojevima, kao tupfer, rola i drugo.
• Aktivira se na većim površinama
• 10 tankih slojeva
• Bez imunološkog potencijala

• Uporaba u ortopedskoj, kardiovaskularnoj, neurokirirgiji i vaskularnoj kirurgiji
• Postizanje brže hemostaze u usporedbi sa standardnim hemostatikom
• Lako uklanjanje i repozicioniranje
Netkani materijal povećava kontaktnu površinu sa područjem krvarenja
Proizvod je pojedinačno pakiran u nepropusnu foliju, 10 ili 12 kom /kut., veličine: od 2,6x2,6 cm (najmanja veličina) do 15,2x22,9 cm (najveća veličina).
Netkana oksigenirana regenerirana celuloza
Netkani, iglom perforirani, sterilni, materijal, 100% biljnog porijekla.
• Postizanje brže hemostaze u usporedbi sa Standardom
• Lako uklanjanje i repozicioniranje

Netkani materijal povećava kontaktnu površinu sa područjem krvarenja
Proizvod je pojedinačno pakiran u nepropusnu foliju, 10 ili 12 kom /kut., veličine: od 2,5x5,1 cm (najmanja veličina) do 10,2x10,2 cm (najveća veličina).
Polymeshpolipropilenske mrežice
• Pleteni polipropilen, monofilament
• Vrhunska biokompatibilnost i brzo zacjeljivanje


• Različiti raspon težina i veličina mrežica (28 g/m², 50 g/m²,85g/m², vel. od 4,5x10cm do 30x30 cm)
Polymeshcomposite
• Djelomično resorbirajuća kompozitna mrežica, od resorptivnog PGAPCL i neresorptivnog polipropilena

Polymesh - dual
• Dvostrana kirurška mrežica, netkani materijal presvučen silikonom i polipropilenom.

• Mrežica od dvije vrste materijala sa različitim svojstvima za implantaciju u intraperitoneum.
Polymeshplug & patch
• „Mrežica/čep“ dizajnirana za korištenje kod „tension free“ tehnike

Polymesh - hernia system
• Unaprijed oblikovana, trodimenzionalna mrežca
Polymesh - 3 D
• Unaprijed oblikovana, trodimenzionalna mrežca
PolymeshINOVA



• Mrežica dizajnirana za otvorenu i laparoskopsku operaciju kile, pozicionira se između slojeva tkiva.
• Široki izbor oblika
Poveska za uzimanje krvi s brzom kopčom
Poveska se stavlja iznad mjesta na kojem će se vaditi krv kako bi vena postala vidljivija a time postupak vađenja krvi lakši i ugodniji za pacijenta.
Šifra Opis
12.0.0469.01 plava
12.0.0469.02 crvena
Pumpica za klistiranje
S plastičnom špricom | Šest različitih veličina
Šifra Opis
12.0.0165.00 vel 3 | 40 ml
12.0.0956.00 vel 5 | 89 ml
12.0.0597.00 vel 7 | 143 ml
12.0.1187.00 vel 9 | 224 ml
12.0.0596.00 vel 11 | 347 ml
12.0.1370.00 vel 13 | 483 ml



Prijenosni set za klistiranje
Prijenosni plastični irigator s rasklopivom vrećicom. Također je pogodan za vaginalno ispiranje.

Urološki nelaton kateter | za žene
Urološki kateter po Folleyu - fleksibilna cjevčica koja se umeće u uretru tj. za ispražnjavanje mjehura.
Šifra Opis
10.0.0261.01 CH 10
10.0.0261.02 CH 12
10.0.0261.03 CH 14
10.0.0261.04 CH 16
10.0.0261.05 CH 18

Plastični vaginalni spekulumi za jednokratnu upotrebu
Šifra Veličina
10.0.0299.01 L | 30 mm
10.0.0299.02 M | 26 mm
10.0.0299.03 S | 24 mm
10.0.0299.04 XS | 20 mm
Plastični, sterilni vaginalni spekulumi za jednokratnu upotrebu.


Identifikacijske narukvice
Opis
10.0.5578.00 plava | novorođenčad
12.0.3328.00 roza | odrasli
Irigator set za klistiranje
Kapacitet: 2 litre. Materijal: PVC, gumena cijev. Dva nastavka. Za klistiranje ili vaginalno ispiranje.


Jednokratna britvica

Drvene špatule, 100kom

Folley balon kateter
Folley balon kateter je dvosmjerni kateter s balonom, ima dva oprečna otvora.
Šifra Opis
10.0.3730.01 CH 14
10.0.3730.02 CH 16
10.0.3730.03 CH 18
10.0.3730.04 CH 20
10.0.3730.05 CH 22

Pesar - mekani PVC prsten
10.0.1601.01
10.0.1601.05
10.0.1601.13
10.0.1601.14
10.0.1601.15

Pesar je prsten od mekanog PVC materijala koji se postavlja u rodnicu u svrhu podizanja spuštene maternice i spriječavanja inkontinencije. Pesar podiže prednju stijenku rodnice, vrat mokraćnog mjehura a time i mokraćnu cijev.
NITRILNE rukavice s teksturom dijamanta | 50 kom
VELO STRONG nitrilne rukavice s teksturom dijamanta u narančastoj boji. Rukavice pružaju zaštitu od kemikalija u skladu s EN ISO 374-1 te od mikroorganizama u skladu s EN ISO 374-5.
Šifra Veličina
VELO-5049102 S
VELO-5049103 M
VELO-5049104 L
VELO-5049105 XL
VELO-5049106 XXL

NITRILNE rukavice | bez pudera COATS premaz od koloidne zobi | SVIJETLO PLAVE | 200 kom
Šifra Veličina
BEC-50405002 S
BEC-50405003 M
BEC-50405004 L
BEC-50405005 XL



Nitrilne dijagnostičke rukavice s unutarnjim zaštitno-hidratantnim slojem koji sadrži prirodnu koloidnu zob kao sredstvo za zaštitu kože. COATS® je akronim za **Colloidal Oatmeal System** – patentiranu tehnologiju premaza za rukavice koja sadrži klinički dokazanu koloidnu zob za zaštitu kože. CERTIFICIRANE BEZ GLUTENA, sigurne za osobe s celijakijom ili osjetljivošću na gluten. Koloidna zob navedena je kao uobičajeni naziv sastojka za upotrebu u označavanju kozmetičkih proizvoda prema Odluci Komisije (EU) 2019/701 od 5. travnja 2019. godine.
Izvanredna sposobnost prihvata i držanja zahvaljujući posebnoj teksturi. Izrađene od materijala koji osigurava trajnost i fleksibilnost. Omogućava cirkulaciju zraka, što minimizira znojenje ruku.
Šifra Veličina
VELO-5049002 S
VELO-5049003 M
VELO-5049004 L
VELO-5049005 XL
VELO-5049006 XXL

NITRILNE rukavice | bez pudera | CRNE | 100 kom
Šifra Veličina
VELO-5046202 S
VELO-5046203 M
VELO-5046204 L
VELO-5046205 XL

Pregledne jednokratne zaštitne rukavice izrađene od nitril-butadien gume (NBR), bez pudera, nesterilne imaju slična svojstva i karakteristike koje odgovaraju rukavicama od prirodnog lateksa. U skladu s regulativom za medicinske uređaje 2017/745, EN 455, regulativom za osobnu zaštitnu opremu 2016/425, EN ISO 21420, EN (ISO) 374, EN 16523-1. Univerzalnog su oblika tako da odlično pristaju na lijevu i desnu ruku. Napravljene su bez prirodnog lateksa.
NITRILNE rukavice | bez pudera | RUŽIČASTE | 100 kom
Šifra Veličina TOW020945 XS TOW020946 S TOW020947 M


Namjenjeno korištenju u liječničkim ordinacijama, stomatološkim ordinacijama, kozmetičkim salonima, frizerskim salonima i dr. Pruža zaštitu od kemikalija kao zaštitna rukavica tipa B u skladu s EN ISO 374-1. Ispitano na prodor mikroba u skladu s EN 374-5. Rukavice imaju teksturirane vrhove prstiju čime omogućavaju čvrsto prianjanje kod hvata pri radu. Ove rukavice odgovaraju i desnoj i lijevoj ruci.
SemperCare NITRILNE rukavice | bez pudera | PLAVE | 100 kom
Šifra Vel
SEM-3000012742 XS
SEM-3000012743 S
SEM-3000012744 M
SEM-3000012745 L
SEM-3000012746 XL


Mekani materijal koji je razvijen u Semperit europskom istraživačkom centru omogućava maksimalan osjećaj dodira i udobnost zahvaljujući optimiziranoj debljini stijenke, a istovremeno pruža maksimalnu zaštitu od infekcija. Štiti korisnike i pacijente od prijenosa infekcija prema EN 455-1. Osim zahtjeva za nepropusnost europskog standarda, rukavice također ispunjavaju zahtjeve za nepropusnost virusa prema ASTM F 1671. Materijal rukavice otporan je na krv i druge tjelesne tekućine te štiti od bakterija, gljivica i virusa, uključujući SARS-CoV-2, hepatitis B i C te HIV.
LATEX rukavice | s puderom | BIJELE | 100 kom
Šifra Veličina
1000-LP S
1000-LM M
1000-LG L
24-1020 XL

Zaštitne rukavice od lateksa za jednokratnu upotrebu, s puderom. specifična izrada za jednostavno rukovanje i spriječavanje pomicanja. Teksturirano za poboljšano prianjanje. Niska razina ekstaktabilnih proteina i kemijskih ostataka. Prikladno za korištenje tijekom rukovanja hranom (food safe). Rukavice imaju sloj prekrivnog pudera. Hipoalergene i ambidekstrozne. U skladu s EN 455. Proizvedeno u skladu s međunarodnim standardom kvalitete ISO 9001, ISO 13485.

LATEX rukavice | bez pudera | BIJELE | 100 kom
Šifra Veličina
VELO-5040601S XS
VELO-5040602S S
VELO-5040603S M
VELO-5040604S L
VELO-5040605S XL


Velo lateks pregledne rukavice bez pudera namijenjene su jednokratnoj uporabi, rukavice su nesterilne. Dizajnirane su za širok raspon primjena, kao što je na primjer dijagnostika ili za osobne potrebe kao dio zaštitne opreme, za rad s hranom. Vanjska površina rukavice je glatka, bez mjehurića i zadebljanja, mikroteksturirani vrhovi prstiju osiguravaju dobar stisak. Razred I sukladno Direktivi o medicinskim proizvodima 93/42/EEC. Kategorija III sukladno Direktivi o osobnoj zaštiti 89/686/EEC. Usklađenost sa standardima: EN 455-1,2,3,4; EN 374-1, 2, 4, 5; EN ISO 374-5; EN 16523-1; EN 388, EN 420:2003+A1:2009; ASTM F 1671. Proizvod je u skladu s uredbom 1935/2004 i odobren je za kontakt s hranom.
Maska za lice troslojna TIP IIR | kirurška | 50 komada | PLAVA
Maska za lice FFP2
Šifra Opis

Medicinska kirurška zaštitna maska za lice TIP IIR za jednokratnu upotrebu, namijenjena je ograničavanju prijenosa zaraznih agensa s osoblja na pacijente tijekom kirurških zahvata i drugih medicinskih aktivnosti sa sličnim zahtjevima. Također je namijenjena pacijentima i općoj populaciji.
BR150-20N/10 10 kom
BR150-20/50 50 kom

Maska je napravljena od višeslojne netkane tkanine za filtriranje po EN 149:2001 + A1:2009 standardima, CE 0068. Ova trodimenzionalna maska je zbog svoje konstrukcije izuzetno ugodna za nošenje i disanje. Na području nosa učvršćuje se pomoću lako savitljive metalne trakice.

Šifra MASKA SYNEK Šifra

OKVIR: 100% polikarbonat (FT). STEM: polikarbonat s fleksibilnim završecima Ecolive®. LEĆA: može se koristiti u ekstremnim temperaturnim uvjetima. DEBLJINA MATERIJALA: Polikarbonat debljine 2,2 mm. BOČNA
ZAŠTITA: široka, učvršćena na okvir. TEŽINA: 45 g. MOGUĆNOSTI: Može se nositi i preko korektivnih (dioptrijskih) naočala! LEĆE: Bistra leća (2-1,2 1FT, klasa filtra svjetlosti: 0). EU standard: CE EN166:2001.
Jednokratni kombinezon s kapuljačom | 5 komada
Šifra Vel
140 40 XL/5 XL
140 40 2XL/5 2XL
Jednokratni kombinezon s kapuljačom | 10 komada
140 40 3XL/5 3XL Šifra Vel 128 35 XL/10 XL 128 35 2XL/10 2XL 128 35 3XL/10 3XL
Zaštitni kombinezon za jednokratnu upotrebu, vodonepropusni, hrvatski proizvod. Gramatura: 40 g/m2, PP + PP film. Zatvaranje kombinezona na zip. Gumice na krajevim rukava i na nogavicama. Zaštitni sloj za odbijanje tekućine. Sirovinski sastav100% polypropilen.

Ogrtač kirurški na vezanje | pakiranje 10 kom
Izrađen je od vodoodbojnog netkanog polipropilena.
Gramatura - 35 g/ m2. Ogrtač ima duge rukave na kojima se nalaze kvalitetne gumice koje sprječavaju neželjeno povlačenje rukava. Dolazi u plavoj boji.

Jednokratni zaštitni kombinezon s kapuljačom, hrvatski proizvod. Gramatura: 35 g/ m2. Zatvaranje kombinezona na zip. Gumice na krajevim rukava i na nogavicama.

Ogrtač kirurški na vezanje | pakiranje 10 kom
Izrađen je od vodoodbojnog netkanog polipropilena (PP + PP film). Gramatura - 40 g/m2. Dolazi u bijeloj boji. Pakiranje - 10 komada u paketu.

Komplet pri porodu za posjetitelje
Komplet za očeve i članove obitelji koji žele prisustvovati porođaju. Komplet uključuje: gornji dio, hlače, medicinsku kapu, 1 masku za lice, 2 navlake za cipele plave boje.

Kapa kirurška na čičak
Gramatura - 35 g/m2. Kapa se kopča pomoću čička. 10 kom.

Kapa kirurška na vezanje
Gramatura - 35 g/m2. Kapa se može optimalno podesiti pomoću vezica na vratu. 10 kom.

Kapa kirurška na vezanje sa silikonom i znojnikom
Gramatura - 35 g/m2. 10 kom.



START Sklopiva invalidska kolica
Šifra Širina sjedišta | Boja
CP100B-40 40 cm | plava
CP100B-43 43 cm | plava
CP100B-45 45 cm | plava
CP100B-46 46 cm | plava
CP100B-48 48 cm | plava
CP100R-40 40 cm | crvena
CP100R-43 43 cm | crvena
CP100R-45 45 cm | crvena
CP100R-46 46 cm | crvena
CP100R-48 48 cm | crvena
Stabilni okvir od obojenog čelika, sjedalo i naslon u crnom najlonu, podstavljeni i perivi. Džep za dokumente na stražnjoj strani. Stražnji kotači napravljeni od aluminija, s crnim PU gumama bez zračnica i rukohvatom od obojenog čelika. Crni PVC prednji kotači s čeličnom vilicom. Kratki sklopivi nasloni za ruke s crnom oblogom. Uklonjivi nasloni za noge podesivi po duljini s crnom plastičnom pločom za nogu i remenom za petu. Maksimalna nosivost: 120 kg. Težina kolica: 17,5 kg.


TRAVEL Sklopiva putna kolica
Šifra
CP850-37
Sjedište i naslon od podstavljenog najlona sa stražnjim džepom. Gume fi 20 cm / fi 13 cm. Sklopivi rukohvati. Okvir od anodiziranog aluminija u srebrnoj boji. Sigurnosni pojas. Sjedište 37 cm. Sklopive dimenzije: 66x29x60 cm. Nosivost 75 kg. Težina kolica: 7 kg.


HELIOS ACT Lagana i sklopiva invalidska kolica
Šifra Širina sjedišta
CP780-40
CP780-43
CP780-46
CP780-48
CP780-50
HELIOS PRO Lagana i sklopiva invalidska kolica idealna za USKE prolaze
Šifra Širina sjedišta
CP790-40
CP790-43
CP790-46
CP790-48
CP790-50

Helios Act su lagana, čvrsta i sklopiva invalidska kolica aluminijske konstrukcije koja imaju sklopive i uklonjive naslone za ruku. Stražnji kotači promjera 61 cm nalaze se na osovini koju je moguće podesiti u više položaja i opremljeni su sa zaštitom protiv bušenja dok su podesivi prednji PVC kotači promjera 20 cm. Helios Act invalidska kolica idealna su za uske prolaze. Standardna oprema uključuje podesivu prednju vilicu kolica I nagibni naslon za noge. Maksimalna nosivost: 120 kg. Težina kolica: 15,6 kg.
SKINNY GO Invalidska kolica za bolnički prijevoz

Sklopivi i uklonjivi nasloni za ruke podesivi su po visni i dubini. Stražnji kotači promjera 61 cm nalaze se na osovini koju je moguće podesiti u više položaja. Prednji PVC kotači promjera 20 cm. Prednja vilica kolica također je podesiva u više položaja. Podstavljeni naslon sjedala podesiv je u 3 točke dok je sjedalo podesivo po dubini. Standardna oprema uključuje podesivu prednju vilicu kolica, nagibni naslon za noge i podesive ručke za guranje kolica. Maksimalna nosivost: 130 kg. Težina kolica: 16 kg.
PLUS Sklopiva invalidska kolica za pretile pacijente
Šifra Širina sjedišta CP300-50

Sjedište 43 cm. Okvir od bojanog čelika, naslon i sjedište od perivog najlona. Stražnji džep. Odvojivi rukohvati. Podesivi po visini i odvojivi nasloni za noge. Stražnji kotači 30 cm, prednji kotač 18 cm. Nosivost: 110 kg.
KIDDY Dječja sklopiva kolica

Sjedište 35 cm. Presvlaka od najlona. Rukohvati i naslon za noge podesivi po visini. Čelični okvir. Težina 14,5 kg. Gume fi 56/15 cm. Nosivost 100 kg. Dimenzije: 94 x 35 x 86cm.
Širina sjedišta 60 cm. Okvir od bojanog čelika, dupli X, naslon i sjedište od perivog najlona. Stražnji džep. Odvojivi rukohvati. Podesivi naslon za noge. Stražnji kotači 60 cm, prednji kotači 20 cm. Nosivost: 200 kg.


Šifra Širina sjedišta | Nosivost
REHA-PP40
REHA-PP42
REHA-PP44
REHA-PP46
REHA-PP49
REHA-PP52

Invalidska kolica sa sklopivim okvirom, sklopivim naslonima za ruke te uklonjivim i po visini podesivim naslonima za noge. Dostupan sa 24” stražnjim kotačima s punom PU gumom, 8” plastičnim prednjim kotačima s punom PU gumom. Tkanina za sjedalo od podstavljenog najlona sa stražnjim džepom na leđima (dostupna u vatrootpornoj verziji na zahtjev) i sigurnosnim pojasom. Priključak za vilice s pojačanjem. Kolica dolaze s jednostrukim križnim okvirom.
Sklopiva aluminijska invalidska kolica s dvostrukim križnim nosačem. Stražnji kotači: 24” s čvrstim PU gumama s funkcijom brziog otpuštanje i promjenjivog pozicioniranja, opremljeni su aluminijskim rukohvatima i parkirnom kočnicom. Prednji kotači su veličine 7,5” postavljeni na aluminijsku vilicu s mogućnošću podešavanja u tri položaja za promjenu visine sjedala. Mali kotači za uske prolaze. Podesive kočnice s aluminijskom polugom. Naslon za leđa sa stražnjim džepom i sjedalo su podstavljeni i izrađeni od najlona. Uklonjivi oslonci za noge opremljeni su remenom za petu, imaju mogućnost rotacije naprijed-natrag i podešavanje visine. Nosivost 120 kg. Težina kolica: 15 kg. REHAPRIMA
Šifra Širina sjedišta
E-LIGHT-40P
Šifra Širina sjedišta | Nosivost
REHA-CP40
REHA-CP44
REHA-CP46
REHA-CP49
REHA-CP52

Sklopiva invalidska kolica RehaComfort REHA-CP49 namijenjena su teško pokretnim osobama koje se ne mogu samostalno kretati. Opremljena su sa sklopivim naslonima za ruke s PU podstavom i uklonjivim te po visini podesivm osloncima za noge. Stražnji kotači su veličine 24” s punom PU gumom i sustavom brzog otpuštanja dok su prednji kotači plastičnog profila i veličine 8” x 2” opremljni s punim PU gumama. Parkirne kočnice dolaze s čeličnom polugom. Tapecirano sjedalo opremljeno sa džepom sa stražnje strane lako se održava.
Sklopiva invalidska kolica Sklopiva invalidska kolica JNEC-874 A
Šifra Širina sjedišta

Robustan okvir od kromiranih čeličnih cijevi. Naslon i sjedalo od snažne najlonske tkanine. Sklopiva kolica. Gumeni kotačići. Nosivost: 110 kg.

Dimenzije: 65 x 91 cm. Širina sjedala 46 cm. Masa: 20 kg.
Kolica su sive boje i opremljena su jednim križem, uklonjivim naslonima za ruke koji olakšavaju pokrete pacijenta i stražnjim ručkama za pomoć pri guranju. Stražnji kotači promjera 20” prednji kotači promjera 7” s funkcijom zakretanja. Oslonci za noge


su rotirajući, uklonjivi i podesivi po visini. Kolica su čeličnog okvira. Stražnji kotači sa žbicama i punim PU gumama te prihvatom od aluminija. Prednji kotači s punim PU gumama. Nasloni za ruke od poliuretana. Nosivost: 120 kg. Težina kolica: 16 kg.

FORMAT 3.940 sklopiva lagana invalidska kolica
HZZO šifra: 1221060709010
Šifra Širina sjedišta
Format3.940-40 40 cm
Format3.940-43 43 cm
Format3.940-46 46 cm
Format3.940-48 48 cm
Format3.940-51 51 cm
Sklopiva lagana invalidska kolica FORMAT 3.940 poznate njemačke tvrtke MEYRA mogu se optimalno prilagoditi svom korisniku i imaju visoku udobnost sjedenja zahvaljujući ergonomskom dijelu leđa s lumbalnom krivinom. Uglavnom se koristi u kućnom i bolničkom sektoru, ali i u gerijatrijskoj skrbi. Promjenjiva visina prednjeg dijela sjedala. Podesiva napetost naslona za leđa. Bočna stranica se može skinuti i preklopiti.Zakretni i uklonjivi nasloni za noge. Oslonci za stopala podesivi po kutu. PU nebušive pune gume. Uzak razmak između obruča i naplatka. Silverline boja okvira. Pogodne za transport pacijenata, bolničku i gerijatrijsku skrb te kućnu upotrebu. Testirano prema ISO 7176-19. Nosivost: 130 kg. Težina kolica: 17 Kg.

Netti 4U CE invalidska kolica
HZZO šifra: 1221030712010

Netti 4U CE je ekonomičan model invalidskih kolica idealan za ustanove, kućnu upotrebu i gerijatrijske pacijente kojima su potrebne česte promjene položaja. Invalidska kolica dostupna su u širinama sjedala od 400, 450 i 500 mm (po širini fleksibilna do 40 mm) i namijenjena su za korištenje osobama do 135 kg težine. Dug vijek trajanja i petogodišnje jamstvo na okvir garancija su kvalitete i izdržljivosti Netti 4U invalidskih kolica. Netti 4U CE invalidska kolica karakterizira lagani i uski dizajn što ih čini idealnim za uska vrata i tijesne zatvorene prostore. Dubina sjedala može se jednostavno podesiti bez zamjene dijelova za ukupno 7,5 cm jednostavnim podešavanjem. Naslon za leđa je ergonomskog oblika, a integrirane bočne potpore drže trup stabilnim. Podešavanje kuta naslona do 45 ° i nagiba sjedala do 20 ° osigurava dovoljno prostora za promjenjive položaje sjedala. Radi lakšeg ustajanja, sjedalo se može nagnuti 5 ° prema naprijed.
Rolator LONDRA TOP special edition | narančasti

Sklopivi aluminijski okvir - čvrst i lagan. Ergonomske ručke podesive po visini. Udobno sjedalo od polipropilena. Podstavljena prečka za naslon s udobnom EVA podstavom. Širina sjedala: 37 cm. Ukupna širina: 58,20 cm. Visina sjedala: 46,60 do 53,80 cm. Podešavanje visine ručke: 78,50 do 97,50 cm. Promjer kotača: 14,50 cm. Težina: 6,8 kg. Nosivost: 136 kg
Rolator MONTREAL TOP special edition | narančasti

Lagan i čvrst sklopivi aluminijski okvir omogućava ugodno kretanje i lako upravljanje. Ergonomske ručke rolatora lako su podesive po visini. Udobno sjedalo od polipropilena omogućava korisniku odmaranje i pauzu. Podstavljena prečka za naslon s mekom EVA podstavom. Torba za pohranu koja se postavlja ispod sjedala poslužit će za spremanje osobnih stvari ili stvari iz trgovine. Držač štapa. Širina sjedala: 37 cm. Ukupna širina: 59 cm. Visina sjedala: 52,50 do 57 cm. Podešavanje visine ručke: 89,60 do 98,30 cm. Promjer kotača: 20 cm. Težina: 10 kg. Nosivost: 136 kg
Rollator s dva prednja fiksna kotača opremljen u osnovnoj konfiguraciji: sklopivi čelični okvir, čvrsto podstavljeno sjedalo, ručke podesive po visini, čvrste PU gume. Širina sjedala: 45,5 cm, ukupna širina: 60,5 cm, visina sjedala: 53,5 cm, podešavanje ručki: 83-95 cm, promjer kotača: 13 cm, debljina kotača: 2,5 cm, težina: 5,5 kg, maksimalno opterećenje: 100 kg.

Rolator sa sklopivom aluminijskom konstrukcijom s četiri kotača, okretna sprijeda i fiksna stražnja s parkirnom kočnicom. Sklopivi aluminijski okvir, podstavljeno sjedalo, podstavljena šipka za naslon za leđa, ergonomske ručke podesive po visini, metalna košara za predmete. Širina sjedala: 34 cm, ukupna širina: 58 cm, visina sjedala: 55 cm, podešavanje ručki: 89-97 cm, promjer kotača: 15 cm, debljina kotača: 2 cm, težina: 7,2 kg, maksimalno opterećenje: 135 kg.

Rolator MONACO 2 u 1 funkcija rolator i transportna kolica

Sklopivi aluminijski okvir. Ergonomske ručke podesive po visini. Lako dostupne ručice kočnice. Podstavljena površina sjedala s fleksibilnom trakom za naslon. Nasloni za ruke. Sklopivi oslonac za noge (rolator se može koristiti i kao transportna kolica). Torba za pohranjivanje smještena ispod površine sjedala. Držač štapa. Lagano se sklapa - lako pospremanje i priprema za transport. Širina sjedala: 77 cm. Ukupna širina: 63 cm. Visina sjedala: 52 cm. Podešavanje visine ručke: 84 cm. Promjer kotačastražnjih kotača: 20 cm. Promjer prednjih kotača: 25 cm. Težina: 8,80 kg. Nosivost: 136 kg.
Rollator ROMA

Rolator s okretnim prednjim kotačima i fiksnim stražnjim kotačima s kočionim sustavom, opremljen u osnovnoj konfiguraciji: sklopivi čelični okvir, plastični pladanj, metalna košara, čvrsto podstavljeno sjedalo, parkirna kočnica, ručke podesive po visini, čvrste PU gume. Širina sjedala: 42 cm, ukupna širina: 59 cm, visina sjedala: 61 cm, podešavanje ručke: 78,5 - 93 cm, promjer kotača: 20 cm, debljina kotača: 5 cm, težina: 9,1 kg, maksimalno opterećenje: 120 kg.
Rolator TORONTO
5%
Sklopivi aluminijski rolator s dva okretna prednja kotača ø 200 mm i stražnjim kotačima ø 200 mm, opremljen kočnicama. Sjedalo od polipropilena. Ergonomske ručke rolatora lako su podesive po visini. Podstavljena prečka za naslon s mekom EVA podstavom. Torba za pohranu koja se postavlja ispod sjedala. Držač štapa. Širina sjedala: 36 cm. Ukupna širina: 63,8 cm. Visina sjedala: 50,5 do 57,5 cm. Podešavanje visine ručke: 88,7 do 100,5 cm. Promjer kotača: 20 cm. Težina: 9 kg. Nosivost: 136 kg.
Rolator NEW VIENNA

Sklopivi aluminijski rolator VANCOUVER

Sklopivi aluminijski rolator Vancouver opremljen je s dva okretna prednja kotača ø 200 mm i stražnjim kotačima ø 200 mm, opremljenima kočnicom. Ergonomske ručke podesive su po visini i opremljene su s polugama kočnice. Rolator je također opremljen sjedalom i polutvrdim naslonom za leđa. Okvir rolatora ima dvostruki sistem preklapanja, povlačenjem ručke sjedala prema gore dolazi do automatskog zatvaranja križa i istovremeno preklapanja nogu, kako bi se što više smanjile ukupne dimenzije prilikom transporta. Ukupna širina: 64,9 cm. Korisna širina: 50 cm. Širina sjedala: 43,2 cm. Dubina sjedala: 28 cm. Visina sjedala: 49,2 cm. Podešavanje visine ručica: 86,3 - 99 cm. Promjer prednjih i zadnjih kotača: 20 cm. Težina: 9 kg. Nosivost: 136 kg.
Aluminijski rolator i kolica za kupnju | ORLANDO

Rolator s konstrukcijom aluminijskih kolica za kupnju na četiri kotača, od kojih su prednji promjera 25 cm a zdanji 20 cm. Stražnji kotači opremljeni su sa sustavom kočenja. Ručka za guranje podesiva je po visini i opremljena je s jednostavnom ručicom kočnice. Na rolatoru kolicima za kupnju nalaze se dvije torbe. Prednja torba s patentnim zatvaračem velikog je kapaciteta. Stražnja mrežasta torba otvorena je na vrhu i manje je zapremnine. Ukupna širina: 54,3 cm. Podešavanje visine: 85 - 103 cm. Promjer prednjih kotača: 25 cm. Promjer zadnjih kotača: 20 cm. Težina: 7 kg. Nosivost: 136 kg.
Sklopivi lagani rolator od karbona | DAYTONA

5%
Sklopivi aluminijski rolator s četiri kotača, dva zakretna prednja kotača i dva fiksna stražnja kotača sa sustavom kočenja. Ergonomske ručke rolatora lako su podesive po visini. Udobno sjedalo od polipropilena omogućava korisniku odmaranje i pauzu. Podstavljena prečka za naslon s mekom EVA podstavom. Torba za pohranu. Širina sjedala: 37 cm. Ukupna širina: 63,6 cm. Visina sjedala: 53,7 do 60,8 cm. Podešavanje visine ručke: 93 do 101,7 cm. Promjer kotača: 20 cm. Težina: 9 kg. Nosivost: 136 kg

Lagani rolator sa sklopivom karbonskom strukturom postavljen je na četiri kotača od kojih su prednji okretni kotači 25 cm promjera dok zadnji dolaze s kočionim sustavom i promjera su 20 cm. Ergonomske ručke Daytona karbonskog rolatora podesive su po visini i opremljene su s ručicama ručne kočnice. Rolator dolazi s poprečno sklopivim okvirom, najlonskim sjedalom i trakom za naslon za veću udobnost. Vreća za pohranu s držačem štapa smještena je ispod površine sjedala. Ukupna širina: 64,1 cm. Širina sjedala: 45 cm. Podešavanje visine: 86 - 95,8 cm. Promjer prednjih kotača: 25 cm. Promjer zadnjih kotača: 20 cm. Težina: 7 kg. Nosivost: 136 kg.
Mrežica za rolatore/kolica
Pamuk. Za invalidska kolica, hodalice i rolatore. Nosivost do maksimalno 5 kg. Perivo do 30 °C. Dimenzije: 35x35 cm.
Sklopiva aluminijska hodalica
Šifra
AD-40N
5% PDV
Fiksna. Okvir od anodiziranog aluminija. Sklapanje na gumb. Poluretanske ručke. Protuklizne gumice. Dimenzije baze: 53x47,5 cm. Visina: 76,5 - 94,5 cm. Masa: 2,4 kg. Nosivost: 135 kg.

Hodalica, gibljiva
Šifra
RP749M
5% PDV
Gibljiva. Sklopiva hodalica na 1 gumb. Izrađena od laganog anodiziranog aluminija. Podstavljeni rukohvati, protuklizne gumice. Podesiva visina na svaka 2,5 cm od 82 do 92 cm. Dimenzije baze: 52-56 cm (š), 51 cm (d). Najveće opterećenje: 130 kg.


Štapovi za hodanje
Preklopivi štap za slijepe osobe
Šifra
BC-44
Štap za slijepe osobe, preklopiv u 3 dijela, s gumiranom drškom i sigurnosnim remenom. Izrađen od reflektirajućeg materijala u bijeloj i crvenoj boji za noćnu vidljivost. Vrh od plastike. Dostupan u 3 varijante duljine.

Hodalica, aluminijska za odrasle s 4 noge
Šifra
RP730M
5% PDV

Fiksna Sklopiva hodalica na 1 gumb. Izrađena od laganog anodiziranog aluminija. Podstavljeni rukohvati, protuklizne gumice. Podesiva visina na svaka 2,5 cm od 73 do 83 cm. Dimenzije baze : 58-61 cm (š), 46 cm (d). Najveće opterećenje: 130 kg.
Hodalica s 2 kotačića
Šifra
11.0.5725.00
5% PDV
Sklopiva hodalica izrađena od laganog aluminijskog okvira s gumenim čepovima protiv klizanja. Podesiva visina 72-98 cm. Težina: 3 kg. Kapacitet: 100 kg. Dimenzije: 760-940 mm.

Rezervne gume za hodalice
RP730M, RP749
Šifra
RV7030
5% PDV
Sive boje, promjer 2,8 cm. Par guma.


Štaka podlaktna | jedno rastavljanje | razne boje
Šifra Boja
KDK-89 CRN crna
KDK-89 CRV crvena
KDK-89 LJUB ljubičasta
KDK-89 PLA plava
KDK-89 SIV siva
Nosivost: 150 kg. Cijena je za 1 komad.

Hvataljka s malim magnetom
Šifra
AU120

Aluminijska hvataljka s rotirajućom glavom i malim magnetom za prikupljanje metalnih predmeta. Duljina: 75 cm. Nosivost 2 kg. Duljina 76 cm + 15,5 cm glava.
Podlaktična dječja štaka na dva rastavljanja - multikolor
Šifra
KDK-90
Namještanje visine. Dva rastavljanja. Ergonomska ručka za bolji prihvat. Visina se namješta s pomoću štifta na cijevi štake. Nosivost: 100 kg.

Štapovi za hodanje - bukovina Aluminijski štap York
Šifra Opis
RP110 Drvena, zakrivljena
RP130 Drvena, T-drška
Drveni štap od bukovine, dostupan u tri različite varijante po pitanju drške (T-drška i zakrivljena), maksimalne nosivosti do 90 kg. Visina štapa: 92 cm.


Sklopivi štap za hodanje
RP145NL
Štap za hodanje, anodizirani aluminij s protikliznom gumicom. Sklopivi, podesiva visina od 82,5 do 92,5 cm. Drvena drška. Najveće opterećenje: 100 kg.


Štap s 4 noge
Šifra
RP723
Anodizirani aluminij Protuklizne gumice. Štap za odrasle s otvorenom anatomskom drškom. Podesiva visina od 75 do 95 cm - opterećenje do 130 kg.

Čelični štap za hodanjeBrio HD serija
Šifra Boja
AD-33B plavi
AD-33G sivi
AD-33N crni
Aluminijski štap s T drškom od mekanog poliuretana sa sigurnosnom trakicom oko zgloba i protukliznom gumicom. Podesiv po visini u 10 točaka od 75 do 98 cm. Nosivost: 113 kg. Dostupan u 3 boje: plava, siva i crna.

Štap za hodanje za
djecu s 3 noge
Šifra
RP715
Anodizirani aluminij. Protuklizne gumice. Štap za djecu sa zatvorenom anatomskom drškom i velikom stabilnom bazom. Podesiva visina od 66 do 73 cm - opterećenje do 80 kg.

Potporni štap s 4 noge
Šifra
RH720
Izrađen od čelika, protuklizne gumice. Podesiva visina: od 74 do 97 cm. Najveće opterećenje: 226 kg. Težina štapa: 1.450 grama.

Aluminijski sklopivi
štap - Bristol
Šifra Boja
AD-32M smeđi
AD-32N crni
Aluminijski sklopivi štap s drvenom derby ručkom. Lako podesiva visina pomoću osovine za zaključavanje. Gumeni vrh i plastično kućište. Dostupan u dvije različite boje.

Štap s 3 noge
Šifra
RP721
Anodizirani aluminij. Protuklizne gumice. Štap za odrasle sa zatvorenom anatomskom drškom. Podesiva visina od 74 do 97 cm - opterećenje do 130 kg. Dimenzije baze 30 x 21 cm.

Sklopivi aluminijski štapovi podesive visine
Šifra
AD-80 Šifra RH150
Podesiva visina: 7497 cm. Maks. nosivost: 226 kg.

Sklopivi aluminijski štapovi s raznim uzorcima, te s crnom drvenom drškom. Visina od 76 do 99 cm, nosivost 113kg. Gumeni vrh za sigurnije kretanje.



KDK-106 Guma za štaku crna / siva / žuta 16 /18 / 22
KDK-116 Guma za štaku crna / siva / žuta 16 /18
RV7033
RV4452
Rezervne gume za štap s 4 noge RP723
Zamjenska guma za štap RP130, RP132, RP135, RP110






Sklopiva toaletna kolica
Šifra RC320-43
Udobna kolica sa sklopivim okvirom od čelika premazanog epoksidnim prahom otpornim na hrđu. Nepomično sjedalo i naslon, anatomski oblikovani i uklonjivi bez alata. Obloga od vodoodbojne plave kože i podstava od vatrostalnih materijala ispitanih prema standardima EN 1021-1 i EN 1021-2. Nasloni za ruke od PU. WC posuda koja se može skinuti i prati.Prednja rupa u obliku slova U. Sklopivi, uklonjivi i podesivi oslonci za noge, remen, 4 okretna kotača od kojih 2 s kočnicama.

Invalidska toaletna i tuš kolica s malim kotačima
Šifra RS940
Okvir od anodiziranog aluminija, nasloni za ruke s nagibom, odvojivi i podesivi nasloni za noge koji se mogu zakretati. Podstavljeno sjedalo i naslon. 4 okretna kotačića s kočnicama (Ø 10 cm). Dubina jastučića 5,5 cm. WC otvor dimenzija 22 cm

Zamjenska posuda s poklopcem i ručkom za toaletna kolica RC320-43

Invalidska toaletna i tuš kolica
Šifra RS941
Kolica za tuširanje s toaletnim dodatkom. Aluminijski okvir. Sklopivi nasloni, odvojivi i po dužini podesivi nasloni za noge. Podstavljen naslon i sjedište. Prednji kotači 20 cm, stražnji 62 cm.
Šifra 16.0.5845.00 Šifra
Zamjenska posuda s poklopcem i ručkom za toaletna kolica RS940

Zamjenska posuda s poklopcem i ručkom za toaletna kolica RS941

Toaletna kolica TRS-130

Podesiva toaletna stolica s podesivim osloncem za noge (u 4 pozicije) i skidajućim naslonima za ruke i naslonom za leđa. Kotačići od nehrđajućeg čelika s kočnicama na 2 zadnja kotačića. Kapacitet: 130 kg, težina 14,5 kg.


4-u-1 Toaletni stolac
prilagodljive visine i nosivosti
5% PDV
4 protuklizne gumice. Podesiva visina sjedala: 45 do 55 cm. Ukupno podesiva visina: 66 do 76 cm. Donje dimenzije: 65x46 cm. Nosivost: 130 kg. 4 funkcije: toaletno povišenje, toaletni stolac, sigurnosna ograda za toalet i stolac za tuš.

Rezervni dijelovi za toaletni stolac RP780
RV7058-4
RV7069-5
RV7024
Toaletna daska s poklopcem (RV7058-4)
Posuda s poklopcem i ručkom (RV7069-5)
Gumice, 4 kom, fi 28,5 mm (RV7024)


Okrugli stolac za tuširanje

Tapecirani toaletni stolac
Šifra Širina sjedišta
RC300-43 43 cm
RC300-45 45 cm
RC300-48 48 cm
5% PDV

Laka prilagodba visine, mogućnost namještanja iznad postojeće wc školjke, zasebnog korištenja kao toaletne stolice jer je opremljena uklonjivom WC posudom s poklopcem i korištenjem kao udobnog stolca za sjedenje najvažnije su prednosti RC300 toaletnog stolca. Čelična konstrukcija toaletnog stolca dostatna je za kosinike do 120 kg težine dok je njena težina svega 11,5 kg što ju čini lakom za prenošenje i manipuliranje.
Sigurnosna ograda za toalet s rukohvatima
Podesiva visina i širina; jednostavno rastavljanje. Obojani čelik, protuklizne gumice na nogama. Dimenzije: 61-69 cm x 43 x 66-76 cm. Nosivost: 100 kg. Težina 3 kg.

Konstrukcija od anodiziranog aluminija. Noge podesive po visini u 8 koraka. Plastično (polietilensko) sjedalo. Nosivost do 110 kg. Non-slip gumene noge. Promjer sjedala 31 cm. Visina sjedala: 36-53,5 cm. Težina tuš sjedala je 1,5 kg.
Stolac za tuširanje | okrugli

Stolac za tuširanje s okruglim sjedištem od polietilena i konstrukcijom od anodiziranog aluminija. Mogućnost podešavanja visine nogu stolca na pet različitih razina od 33 do 50 cm visine. Protuklizni gumeni vrhovi nogu stolca smanjit će mogućnost proklizavanja stolca na mokrim i suhim površinama. Idelano rješenje za kade i tuš kade. Materijal sjedalo: polietilen. Materijal konstrukcije: anodizirani aluminij. Vanjske dimenzije sjedišta: 32 cm. Podešavanje visine u rasponu od: 33 do 50 cm. Vanjski promjer gumenog vrha: 56 mm. Težina: 1,25 kg. Nosivost: 130 kg.
Sklopivi stoliac za tuširanje


Sklopivi stolac za tuširanje. Lako se prenosi. Polietilensko sjedalo s ručkama, emajlirano čelično podnožje. Sjedalo dimenzija 49 x 29 cm. Visina od 47 do 51 cm. Nosivost: 130 kg. Težina: 3,2 kg.
Stolac za tuširanje s pravokutnim sjedištem

Konstrukcija od anodiziranog aluminija. Noge podesive po visini u 8 koraka. Plastično sjedalo od polietilena visoke gustoće. Nosivost do 110 kg. Non-slip gumene noge. Dimenzije sjedala 49,5 x 29 cm. Visina sjedala: 45-62,8 cm. Težina tuš stolca je 1,8 kg.
Stolac za tuširanje s higijenskim izrezom
Stolac za tuširanje s U prorezom bez naslona. Konstrukcija od anodiziranog aluminija. HPDE sjedište dimenzija 48 x 33 cm. Podesiva visina od 41 do 53 cm. Maksimalna nosivost 110 kg. Težina same stolice je 2,3 kg. Jednostavno se sastavlje bez potrebe za uporabom alata.

Stolac za tuširanje s naslonom i higijenskim prorezom
Šifra
RS833
Ovaj praktični stolac za tuširanje ima naslon i higijenski izrez u obliku slova U na sjedalu. Aluminijski okvir osigurava stabilnost i nosivost od 110kg, dok gumene nogice sprečavaju klizanje. Sjedište dimenzija 48 x 33 cm izrađeno je od udobno polipropilena visoke gustoće. Visina je podesiva od 41 do 53,7cm. Jednostavno se sastavlja se bez potrebe za alatom.

Stolac za tuširanje s naslonom
Šifra
RS829
Stolica za tuširanje s naslonom Anodizirani alumnij, HDPE sjedište dimenzija 48x33x 41-53 cm, podesiva visina, protuklizne gumice. Jednostavno slaganje bez upotrebe alata. Dimenzije: 48 x 33 x 41 - 53 cm. Nosivost: 110 kg. Težina: 3 kg.

Klupa za tuš
Šifra Opis
RS919 Klupa za tuš
RV7021 Gumice | 2 kom, Ø17 mm
Plastično sjedalo dimenzija 49 x 28 cm. Noge podesive po visini (38 - 52 cm), obojeni čelik. Nosivost do 100 kg. Neklizajuće gumice promjera 17 mm.


Klupčica za tuširanje, podesiva po visini
Šifra
11.0.5718.00
Podesiva visina: 20-27 cm. Najveće opterećenje: 158 kg. S rupicama za odvod. Dimenzije: 43x23x20-27 cm.

Stolac za tuširanje s naslonom i rukohvatima RS839
Šifra
RS839

Aluminijske je konstrukcije koja podnosi do 110 kg opterećenja. Sjedalo i naslon napravljeni su od polietilena. Podesiv je po visini kako bi se lakše prilagodio potrebama korisnika (8 razina podesivosti). Gumeni podlošci koji se nalaze na kraju nogu stolice sprečavaju klizanje. Jednostavno se sastavlja bez potrebe za alatom.
Stolac za tuširanje s odvojivim naslonima za ruke
Šifra
AB-21
Ovaj stolac za tuširanje je vrlo prilagodljiv jer se nasloni za ruke mogu stavljati i odvajati i može se podešavati i visina sjedišta i visina naslona. Ergonomsko poliuretansko sjedište dimenzije 40x33cm s rupicama za odvod vode. Visina sjedišta je prilagodljiva od 45 do 53cm. Naslon dimenzije 41,5x17cm podesiv je po visini od 36 do 54cm. Nosivost 130kg. Težina 3,1kg. Protuklizne gumice na nogama.

Sjedalo za kadu s regulacijom širine
Šifra Opis
RS925 s naslonom | 53-71 x 37 x 32 cm | 2,5 kg
RS923 bez naslona | 53-71 x 37 x 17 cm | 2 kg
Sjedalo za kadu s regulacijom širine. Čelični okvir. Kapacitet: 100 kg.

Daska za kadu
Šifra Opis
11.0.5801.00 69 cm 16.0.5797.00 74,5 cm


Daska je izrađena od materijala otpornog na vlagu s vodonepropusnim dijelovima. Dolazi s rukohvatom i držačem sapuna. Ima otvore za odvodnju. Jednostavno postavljanje, bez upotrebe alata! Dužina: 69cm / 74,5 cm. Maksimalna nosivost: 150kg.
Rotirajući stolac za kadu
Šifra RS936
Okvir od bijelo bojanog čelika. Inoks sustav za rotaciju. Polipropilensko sjedalo. Dimenzije sjedala: 40x33x38 cm. Dimenzije baze: 73x53x52,5 cm. Težina: 5 kg. Nosivost: 100 kg.
Komplet umivaonik / kadica za pranje kose u krevetu
Šifra
AQ-100


Komplet za pranje kose čine umivaonik (kadica) na napuhavanje sa sustavom za odvod vode te vrećica za vodu sa cijevi za tuširanje koja lako i brzo omogućava pranje kose i glave nepokretnim, teško ili slabije pokretnim osobama.
Kadica za pranje kose u krevetu (HFK)
Šifra
Omogućava pranje kose i glave nepokretnim, teško i slabije pokretnim osobama bez ustajanja iz kreveta.

Električna kolica za kupanje
Šifra Opis
BI110 Električna kolica za kupanje
BIR100 Presvlaka, 68x195x25 cm
BIR110 Otvor za vodu
BIA100 Polukružni jastuk, 55x15x7 cm
Obojan čelični okvir s premazom protiv hrđe. PVC presvlaka dodatno ojačana poliesterom, ber ftalata, s mogućnošću dezinfekcije. Visoki kotači promjera 125mm su opremljeni kočnicama za potpuno zaključavanje. Podesiva visina s pomičnom podlogom za pranje do do 5° a potpuno pražnjenje tijekom i nakon korištenja. Uža širina kolica omogućava lakše rukovanje u manjim prostorima. Strane se mogu pomicati za 180°što omogućava lako premještanje pacijenta s kreveta na kolica i obrnuto. Kapacitet: 200 kg.




Rukohvati za pomoć pri ulasku u kadu
Šifra Opis
SUN-12300 visina: 42 cm | širina: 30 cm
SUN-12305 visina: 41 cm | širina: 34,5 cm
Nehrđajući čelik otporan na koroziju / Plastika.


Gumena podloga za kadu

Bijela. Dimenzije: približno 76x35 cm.
Protuklizne trake i kolutovi



Dostupno u trakama (30 traka, 200 x 20 mm) ili okrugloj varijanti koja se sastoji od 72 koluta promjera 40 mm.
Zaštitne navlake za plivanje, kupanje i tuširanje za ruke i noge
Šifra Opis
AP17 podlaktica | SMALL (43 cm, obujam ≥ 17 cm)
AP21 podlaktica | LARGE (54 cm, obujam ≥ 22 cm)
AP26 ruka | SMALL (66 cm, obujam ≥ 19 cm)
AP31 ruka | LARGE (80 cm, obujam ≥ 26 cm)
LP20 potkoljenica | SMALL (51 cm, obujam ≥ 24 cm)
LP25 potkoljenica | LARGE (64 cm, obujam ≥ 32 cm)
LP33 noga | SMALL (84 cm, obujam ≥ 31 cm)
LP44 noga | LARGE (112 cm, obujam ≥ 47 cm)
Napravljena je od vrlo otpornog poliuretana bez lateksa i namijenjena je višekratnoj upotrebi. Za primjenu nisu potrebna nikakva ljepila niti trake - dovoljno je rastegnuti elastični rub otvora kako bi se zaštitna navlaka za tušrianje mogla navući.




Toaletna povišenja
Šifra Visina | Nosivost
RP400-14 14 cm | do 136 kg

Ergonomski oblikovano sjedalo smanjuje pritisak i pruža veću udobnost prilikom korištenja. Stražnji i prednji otvori omogućuju jednostavno obavljanje osobne higijene.
Toaletna povišenja
Šifra Visina | Opis
RA-210106 6 cm
RA-210110 10 cm
RA-210PZ Poklopac za toaletna povišenja


Može se montirati na sve tipove WC školjki. Ergonomski oblikovano sjedalo smanjuje pritisak i pruža veću udobnost prilikom korištenja. Može se dezinficirati u autoklavu na 85° jednu minutu. Nosivost: do 225 kg.
Mekano i udobno toaletno povišenje
Toaletna povišenja s poklopcem
Šifra Visina RP410-14 14 cm
Može se montirati na sve tipove WC školjki. Ergonomski oblikovano sjedalo smanjuje pritisak i pruža veću udobnost prilikom korištenja. Toaletno povišenje dolazi s poklopcem. Nosivost: do 136 kg.

Toaletno povišenje s centralnim fiksiranjem i ručkama
Šifra Visina RP420 13 cm
Toaletno povišenje za WC školjku i bide izrađeno od EVA plastike. Dimenzije: 46,3 x 34,3 x 10 cm. Težina: 1,5kg.

Komplet rezervnih vijaka za toaletna povišenja Moretti
Šifra
RP431

TSE toaletno povišenje, podesivo po visini
Šifra SUN-15520
Aluminij, plastika, TPR. Podstavljeni i preklopivi naslone za ruke. Ugrađena zaštita od prskanja. Podesiv nagib sjedala. Prikladno za sve standardne WC školjke. Upotrebljivo s ili bez naslona za ruke. Visina sjedala: podesiva u tri stupnja 8 cm / 12 cm / 16 cm. Nosivost 130 kg.

Toaletno povišenje s naslonom za ruke, podesivo po visini
Šifra SUN-15555

Odlično toaletno povišenje koje se lako postavlja na zahod i pruža stabilnost i sigurnost. Nosivost 110kg. Vanjske dimenzije 52x43x13cm.Površina sjedišta 38x41cm. Visina naslona za ruke je 20cm. Težina je 2,5kg.
Plastika. Odvojivi i sklopivi nasloni za ruke. Prikladno za sve standardne WC školjke. Visina sjedala: podesiva u tri stupnja 8 cm / 12 cm / 16 cm. Nosivost 120 kg.

TSE toaletno povišenje s regulacijom visine 8/12/15 cm
Oslonci za ruke (sklopivi). Podešavanje visine: 8, 12 i 16 cm. Napravljeno od kvalitetne ABS plastike. Jednostavno i lagano podešavanje. Pristaje svim standardnim toaletnim školjkama. Ukupna širina - 52 cm. Ukupna duljina - 35,5 cm. Ukupna visina - 49 cm. Maksimalna nosivost - 120 kg. Težina - 4,7 kg.


Posuda urološka i noćna, PVC - lopata
12.0.0131.00 FOR.001.009


Urološka posuda za muškarce s poklopcem i ručkom | guska
Šifra

Noćna posuda s poklopcem potpuno napravljena od inoxa

Urološka posuda za muškarce od inoxa | guska

Noćna posuda s poklopcem


Stolić je opremljen s 4 kotačića, od kojih su dva opremljena s kočnicom. Stolić ima mogućnost podešavanja nagiba te visine pladnja u rasponu od 72 do 115 cm. Dimenzije pladnja u boji drveta: 40 x 60 cm. Težina:7,1 kg. Maksimalno opterećenje: 13 kg. Nagib radne plohe: 90° u obje strane.
Veliki stolić za krevet podesive visine

Stolić za hranjenje s podesivim nagibom, s 4 kotačića, od toga dva s kočnicom. Podesiva visina pladnja: 72-95 cm. Dimenzije pladnja: 57 x 49 cm.
Stolić za hranjenje s kotačićima

Podesiva visina između
70 i 105 cm.
Dimenzije
površine stolića je 60x39 cm.
Težina: 8,5 kg.
Kapacitet 10 kg.

Stolić za hranjenje
Šifra Opis
RS988N fiksni
RS990N podesivi
Stolić za hranjenje s površinom otpornom na ogrebotine, s izdignutim rubom te sklopivim nogama. U boji prirodnog drva. Dostupan u varijanti statičnog stolića te stolića podesivog u tri pozicije. Dimenzije: 60,5x39x24 cm.
Kromirani čelični okvir. 2 podloška, veći je podesiv po nagibu. Ručno podesiva visina od 80 do 117 cm. Površina otporna na ogrebotine s izdignutim rubom. Dimenzije malog podloška: 20x38,5 cm. Dimenzije velikog podloška: 60,5 x 38,5 cm.



Kromirani čelični okvir s podloškom podesivim po nagibu. Površina otporna na ogrebotine s izdignutim rubom. Automatski podesiva visina preko poluge - od 78 do 110 cm. Dimenzije podloška: 76,5x38,5 cm.

Plastični stolići za krevet
M630032
Dimenzije: 58x39x5 cm, bijela plastična tacna. Na sklopivim metalnim nogama. Veliki.

11.0.0549.00
Stolić za krevet sa sklopivim plastičnim nogama.




Nosiva vanjska struktura izrađena od čeličnih profila. Okvir s četiri pomične sekcije izrađen je od čeličnih cijevi s poprečno postavljenim drvenim letvicama i vodilicama. Opremljen je s dva priključka za trapez i nosač infuzije. Sekcija za podizanje glave i sekcija za noge prilagodljive su putem dva električna motora na 24 V DC s kabelskim daljinskim upravljačem koji ima magnetski ključ za aktivaciju. Dio za stopala prilagodljiv je ručno pomoću zupčastog mehanizma. Dio za zdjelicu je fiksan. Uz krevet dolazi trapez s podiznom šipkom, ručkom i prilagodljivim remenom od najlona. Vertikalno podešavanje visine od otprilike 41 cm minimalne visine do 86 cm maksimalne visine. Trendelenburg položaj do 10° i anti-Trendelenburg položaj do 10°. Otpuštanje ograda moguće je putem gumba na uzglavlju. Uklonjivi dijelovi izrađeni od obojenih čeličnih cijevi s kotačima Ø 100 mm i kočnicom, te drvenim pločama kao završnom oblogom. Boja: Bež. Dimenzija ležaja: 200x90 cm. Ukupne dimenzije: 220x105 cm. Ukupna težina: 105 kg. Najveća nosivost: 180 kg.
Barijatrijski električni kreveti Šifra
Šifra Širina

Električni krevet za pretile osobe - do 285 kg nosivosti. Krevet je opremljen s 4-dijelnom zglobnom podnicom s letvicama. Pomoću daljinskog upravljača moguće je prilagoditi podizanje naslona za leđa i naslona za noge kako bi pacijent mogao zauzeti najudobniji položaj. Trendellemburg i Anti-Trendellemburg funkcija. Krevet je opremljen kliznim aluminijskim ogradama, četiri rotirajuća kotača s parkirnom kočnicom te ugrađenom ručkom za pomoć pri ustajanju pacijenata. Dimenzija ležaja: 215 x 132 cm. Ukupna težina: 125 kg. Najveća nosivost: 285 kg.
LT-120B
Tehničke karakteristike:
• Pune dimenzije:
132 x 215 cm
• Dimenzije podnice:
120 x 191 cm
• Visina od tla:
36 do 76 cm
• Težina: 125 kg
• Nosivost: 285 kg
LT-140B
Tehničke karakteristike:
• Pune dimenzije:
152 x 215 cm
• Dimenzije podnice:
140 x 191 cm
• Visina od tla:
36 do 76 cm
• Težina: 135 kg
• Nosivost: 285 kg
Električni krevet za njegu bolesnika
Šifra
LT-M3
LT-M3A

Vanjska nosiva konstrukcija izgrađena od čeličnih profila. Opremljen s dva priključka za stup za podizanje pacijenta i za stalak za infuziju. Uz krevet dolazi montažni trapez s podesivim najlonskim remenom. Električni krevet podesiv po visini (38 - 79 cm) uz pomoć 2 24 V DC elektromotora. Trendelenburg i anti-Trendelenburg podešavanje do 10° uz pomoć žičanog upravljača, zahvaljujući neovisnom kretanju dvaju elektromotora integriranih u naslone. Stranice kreveta - vertikalne klizne, od aluminija, na vodilicama pričvršćene za naslone, s blokadom. Bočno otpuštanje pomoću gumba na stražnjoj strani. Uklonjivo uzglavlje i uznožje od obojene čelične cijevi prekrivene drvenim pločama i opremljene okretnim kotačićima Ø 100 mm s kočnicama. Dimenzija ležaja: 200 x 90 cm. Ukupne dimenzije: 215x102 cm. Ukupna težina: 98 kg. Najveća nosivost: 180 kg.
LT-M3A Električni krevet za osobe s demencijom i Alzheimerovom bolešću
Električni krevet podesiv po visini od 20 cm do 76 cm uz pomoć 2 24 V DC elektromotora - posebno niski položaj kreveta smanjuje mogućnost ozljede oboljeih osoba od demencije.
Električni i zglobni krevet | NEWCARE BARIATRIC
Šifra
NC BARIATRIC
Električni i zglobni krevet sa sustavom podizanja linearnih aktuatora (stupanj zaštite IP66). Ovaj model kreveta pomaže pri rješavanju problema skrbi, liječenja i sigurnosnih pitanja za pacijente do 250 kilograma. Šasija (okvir) kreveta izrađen je od čelika visoke otpornosti s epoksidnim premazom, kako bi se osigurala trajnost i čvrstoća. Linearni aktuatori sa zaštitom IP66. 320 kg sigurnosnog radnog opterećenja. 4 zaštitna odbojnika u svakom uglu. Dvostruki regresijski sustav, smanjuje pritisak u području zdjelice i rizik od dekubitusa. Bočne ograde izrađene od polipropilena sa zonom za hvatanje i sklopivim sustavom pomoću plinske opruge. Centralni sustav kočenja putem pedala smještenih u području uznožja i uzglavlja (2 + 2).


medicinski antidekubitalni madrac s pjenastom podlogom HF6006
Šifra HF6006
Namijenjen za njegu nepokretnih i teško pokretnih osoba te za liječenje pacijenata srednjeg do visokog stupnja dekubitusa. Sprječava nastanak dekubitusa. Poseban dizajn: Donja baza napravljena je od pjenastog materijala debljine 7,5 cm (po potrebi donja baza se može zamijeniti). Gornji dio madraca sastoji se od komora 13 cm visine. Nema potrebe postavljati ga na drugi obični madrac – može se postaviti na bazu kreveta. Funkcija jastukakomore koje se nalaze u području glave su stalno napuhane kako bi se pacijentu omogućio maksimalni komfor. Sta-
Karakteristike madraca:
• Maksimalna nosivost: do 165 kg
• Dimenzije madraca: 200 × 90 x 20,5 cm (donja baza napravljena je od pjenastog materijala debljine 7,5 cm i gornji dio madraca sastoji se od komora 13 cm visine)
Profesionalni
Madrac sa zračnim komorama namijenjen prevenciji, liječenju i terapiji bolesnika višeg stupnja dekubitalnih ozljeda, tipa dekubitusa 3. i 4. stupnja. Sprječava nastanak dekubitusa. Preporučuje se osobama koje su više od 15 sati dnevno vezane uz krevet. Prenosiv / prilagod-
Karakteristike madraca:
• Maksimalna nosivost: do 135 kg
• Dimenzije madraca: 190 × 85 x 11,5 cm
• Materijali: komore od visokokvalitetnog PVC-a medicinske kvalitete (0,3 cm
Karakteristike kompresora (pumpe):
• Ciklus: 12 minuta
• Izlaz zraka: 4-8 L/min
• Raspon tlaka: 50~120 mmHg
Antidekubitalni
Madrac sa zračnim mjehurićima namijenjen za prevenciju i liječenje bolesnika nižeg stupnja dekubitalnih ozljeda, tipa 1 do 2. Sprječava nastanak dekubitusa. Preporučuje se bolesnicima vezanim uz krevet. Prenosiv / prilagodljiv. Mogućnost podešavanja
Karakteristike madraca:
• Maksimalna nosivost: do 130 kg
• Dimenzije madraca: 200 × 90 cm
• Materijali: visokokvalitetan teško
Karakteristike kompresora (pumpe):
• Ciklus: 12 minuta
• Izlaz zraka: 5-7 L/min
• Raspon tlaka: 50~110 mmHg
tična funkcija – sustav se može postaviti u statični mod koji omogućava konstantni tlak zraka u komorama ka ko bi se omogućio rad s pacijentom – prematanja, održavanje higijene i slično. Funkcija postavljanja u sjedeći položaj. Kontrola brzog ispuhivanja u slučaju potrebe za Kardiopulmonalnom reanimaci jom. Mogućnost podešavanja čini ga prilagodljivim gotovo svakom krevetu. Visoko kvalitetna pumpa koja optimalno kontrolira tlak madraca i automatski ga prilagođava težini pacijenta. Audio i vizualni alarm za sigurnost pacijenata.
• Materijali: komore od visokokvalitetnog termoplastičnog poliuretana medicinske kvalitete s rastezljivom PU prekrivkom

• Komore madraca – adaptivne poprečno postavljene ćelije
ljiv. Mogućnost podešavanja čini ga prilagodljivim gotovo svakom krevetu. Visoko kvalitetna pumpa s mogućno šću prilagodbe jačine tlaka. Komplet za popravak, rezer vna komora i fleksibilno crijevo uključeni u pakovanje. ropska tehnologija i kontrola kvalitete ISO 13485.
debljine) s PU prekrivkom
• Komore madraca – 17 adaptivnih poprečno postavljenih ćelija
• Težina madraca: do 4,5 kg
• Napajanje: 220-240V
• Električni uređaji klase II: - zaštita uređaja od električnog udara
• Tihi rad pumpe - gotovo nečujan
Ciklus: 12 minuta
• Izlaz zraka: 6 - 8 litara/minuta
• Raspon tlaka: 20~50 mmHg
• Tihi rad pumpe
ga prilagodljivim gotovo svakom krevetu. Visoko kvalitetna pumpa s mogućnošću prilagodbe jačine tlaka. Komplet za popravak i fleksibilno crijevo uključeni u pakovanje. Europska tehnologija i kontrola kvalitete ISO 13485.
zapaljivi PVC-a medicinske kvalitete, debljine 0,3 mm
• Komore madraca – u obliku mjehurića
• Napajanje: 220-240V
• Električni uređaji klase II: - zaštita uređaja od električnog udara
• Tihi rad pumpe - gotovo nečujan

Šifra Opis
HF6002P Zamjenska pumpa
HF6002M Zamjenski madrac
HF17P Rezervna tuba


HF2002 Antidekubitalni
jastuk s pjenom i zračnim komorama za invalidska kolica
Šifra HF2002

Antidekubitalni jastuk s podlogom od pjene i zračnim komorama za invalidska kolica visokokvalitetni je sustav za smanjenje pritiska koji pruža višu razinu udobnosti za osobe koje dugo sjede. Pomaže smanjiti pritisak raspodjelom težine na širu kontaktnu površinu uz podržavanje kapilarnog krvotoka kako bi se spriječio nastanak dekubitusa.
Tehničke karakteristike:
• Dimenzije: 43 x 43 x 10 cm
• Težina: 2 kg
• Podesivo vrijeme ciklusa, statički/naizmjenični
način rada
• 3 ciklusa
• Nosivost: do 120 kg
• 5 postavki korištenja
• Alarm za niski tlak i alarm prazne baterije
Easy antidekubitalna zaštita
Šifra Opis
CA-205 za lakat
CA-206 za petu i gležanj
Zaštita za sprječavanje dekubitusa lakta, pete i gležnja napravljena od silikonskog šupljeg vlakna smještenog u pamučnu navlaku s Velcro pričvrsnim sustavom. Visoka elastičnost i visoka prozračnost omogućuju učinkovito djelovanje u sprječavanju nastanka rana smanjenjem vršnih tlakova, sila smicanja i trenja. Easy antidekubitalna zaštita za lakat, petu i gležanj namijenjena je pacijentima koji su dugotrajno vezani za krevet.


Naslon za leđa
Šifra
Čelični okvir, prozračna najlonska tkanina s podstavom za naslon glave. Podesiv u 6 različitih pozicija.
Dimenzije: 63 x 55 cm.

Antidekubitalni jastuk 6 cm visine
Antidekubitalna prirodna vuna
Sastavljen je od zračnih ćelija, dizajniran je kako bi osigurao

ravnotežu i zaštitio pacijenta od rizika nastanka dekubitusa i ozljeda tkiva. Prilagođava se obliku tijela korisnika i omogućuje potpuno uranjanje ishiala. Sastoji se od 2 dijela pomoću kojih se vrši podešavanje tlaka zraka u svakom dijelu prema potrebi korisnika. Antidekubitalni jastuk koristi se kako bi se pri sjedenju pravilno pozicioniralo područje zdjelice i udova, smanjio pritisak i spriječio nastanak rana. Opremljen je pumpom za napuhavanje. Dimezije: 40x40 cm. Maksimalna težina: do 130 kg.
Antidekubitalna vuna
Šifra Opis
CO-100.900
CO-100.901
CO-100.902
Sintetička | 50 x 70 cm
Sintetička | 70 x 100 cm
Prirodna | 50 x 100 cm
Zahvaljujući izrazito mekoj i prirodnoj površini pruža dobru razinu prevencije dekubitusa. Prirodna vuna učinkovito djeluje u sprječavanju nastanka rana smanjenjem vršnih tlakova, sila smicanja i trenja te omogućava dobru cirkulaciju zraka. Prirodnu vunu možete položiti na invalidska kolica ili krevet. Također je pogodna i za sve ostale koji žele udobnije i zdravije sjediti i ležati.

Sintetička antidekubitalna vuna napravljena je od polipropilena. Prirodna antidekubitalna vuna od Merino vune. Namijenjena je za prevenciju nastanka rana u postoperativnoj njezi i osobama koje su dugotrajno vezane za krevet. Također je pogodna i za sve ostale koji žele udobnije i zdravije sjediti i ležati.
Antidekubitalna zaštita za petu od sintetičke vune

Zaštita za sprječavanje dekubitusa pete i lakta napravljena od sintetičke vune s Velcro pričvrsnim sustavom. Visoka elastičnost omogućuje učinkovito djelovanje u sprječavanju nastan-
Jastuk protiv hemeroida
Pruža udobnost i potporu pri sjedenju, a može se upotrijebiti kao potpora i za druge dijelove tijela. Jastuk se može ispuhivati i napuhivati prema potrebi. Prikladan je i za putovanja. Antidekubitalan. Promjer jastuka: 45 cm. Napravljen od gume, vrlo izdržljiv.


ka rana smanjenjem vršnih tlakova, sila smicanja i trenja. Antidekubitalna zaštita od sintetičke vune namijenjena je pacijentima koji su dugotrajno vezani za krevet.

Spužvasti jastuk protiv hemoroida
11.0.5652.00
Jastuk u obliku spužvastog prstena sa perivom presvlakom. Promjer 41 cm. Protiv hemoroida i dekubitusa (antidekubitalan). Crvena i zelena boja.

Easy jastuk s otvorom u sredini

Za prevenciju dekubitusa i protiv hemeroida, a izrađen je od silikoniziranih šupljih vlakanaca. Jastuk je također povoljan za sve ostale korisnike koji pate od problema s hemeroidima ili žele udobnije i zdravije sjediti.
Antidekubitalni PVC jastuk | 45 x 45 cm

Osim za sjedalo invalidskih kolica može koristiti i kao naslon za leđa, jastuk za podršku/podlogu kod putovanja, vožnje i dugotrajnog sjedenja tijekom putovanja ili rada. Nosivost: do 120 kg.
Lumbalni oslonac

Pomaže kod smanjenja bolova u leđima pri dugotrajnom sjedenju ili vožnji. Ručno periva navlaka na 30°C. Oblikovani poliuretan, navlaka: 100% poliester. Dimenzije: Dužina 33 cm, Dubina 35 cm, Visina 9/3 cm
Antidekubitalni kolut PVC 40 cm
Mekan i udoban. Idealan je za korištenje nakon poroda, kod hemeroida, nakon kirurških zahvata i za invalidska kolica.
Jastuk s otvorom za trticu

Jastuk s laganim udubljenjem u sredini
Osigurava pravilno držanje kralježnice. Punjenje od poliuretanske pjene s tapecirungom od pamučnog tekstila koji se može skinuti. 45 cm širina x 38 cm dužina x 8 cm visina stražnjeg dijela.

S laganim udubljenjem u sredini za prevenciju dekubitusa izrađen je od silikoniziranih šupljih vlakanaca a smješten je u navlaci. Jastuk je također povoljan za sve ostale korisnike koji žele udobnije i zdravije sjediti.

Opera jastuk za okretanje pacijenta na bok
Anatomski jastuk sa skidivom navlakom

Uz dva polukružna otvora za noge olakšava manevriranje pacijentom i uvelike smanjuje napor koji bi operater mogao osjećati u leđima. Dolazi s pumpom za napuhavanje. Dimenzije*: D: 49 x Š: 40 x V: 15 cm
Preporuča se osobama kojima je potreban jastuk zbog ishijalgije. Oblikovani poliuretan, navlaka: 100% poliester. Dimenzije: Dužina 42 cm, Dubina 38,5 cm, Visina 2,5 - 8,5 cm.

Zakretni jastuk za ustajanje iz kreveta, podizanja sa stolice
Jastuk za noge i koljena, sa skidivom navlakom

Za osobe s poteškoćama u kretanju. Podstavljeno rotirajuće sjedalo s krutom unutranjom konstrukcijom i protukliznom podlogom smanjuje napor korisnika pri podizanju ili ustajanju. Dimenzije: Dužina 44 cm, Dubina 44 cm, Visina 4 cm.
Jastuk za pravilno sjedenje Alvital
16.0.3355.00
Osigurava pravilno držanje kralježnice uz smanjeno opterećenje na nju. Olakšava tegobe prouzročene nepravilnim držanjem tijela. Plava boja.

Ublažava pritisak na donji dio leđa i ugodno pristaje uz obline nogu. Ručno periva navlaka na 40°C. Dimenzije: Dužina 27 cm, Dubina 12 cm, Visina 28 cm.

Idealna za duže sjedenje poput vožnje u autu. Podupire leđa i struk te osigurava parvilno držanje kralježnice.

Električna deka VITAMMY THERMO
Šifra
Dimenzije: 150x80cm. Snaga: 66~60W.
Odvojivi kabel s regulatorom. 3 razine grijanja.

Grijaća dekica za vrat i leđa | 6 razina temperature
Šifra

Grijaća dekica za vrat i leđa. Funkcija automatskog gašenja i 6 razina odabira temperature grijanja. Lako se održava pranjem na 30°C.
Grijaći plašt za vrat i ramena - M | 3 razine temperature
Šifra
Funkcija automatskog gašenja i 6 razina odabira temperature grijanja. Lako se održava pranjem na 30°C. Grijanje se regulira putem urpavljača sa zaslonom s pozadinskim osvjetljenjem. Automatsko gašenje nakon 90 minuta rada.

Grijaća poddeka | dvostruka
Šifra

Automatsko isključenje nakon 3 sata rada. 140×160 cm. 3 postavke temperature s indikatorom razine. Lako održavanje - periva zahvaljujući odvojivom prekidaču. Lako se pričvršćuje na madrac pomoću elastičnih vezica. Napon: 220-240V~50-60Hz. Snaga: 55-60W.
Grijaći pojas za leđa | 3 razine temperature

Funkcija automatskog gašenja i 6 razina odabira temperature grijanja. Lako se održava pranjem na 30°C. Grijanje se regulira putem urpavljača sa zaslonom s pozadinskim osvjetljenjem.
Grijaći plašt - L | 3 razine temperature
Šifra

Funkcija automatskog gašenja i 6 razina odabira temperature grijanja. Lako se održava pranjem na 30°C. Automatsko gašenje nakon 90 minuta rada.
Grijaća dekica | 6 razina temperature
Šifra
Funkcija automatskog gašenja i 6 razina odabira temperature grijanja. Lako se održava pranjem na 30°C. Dekica je napravljena od poliestera. Grijanje se regulira putem urpavljača sa zaslonom s pozadinskim osvjetljenjem.

Grijaći plašt | 6 razina temperature

Funkcija automatskog gašenja i 6 razina odabira temperature grijanja. Lako se održava pranjem na 30°C. Grijanje se regulira putem urpavljača sa zaslonom s pozadinskim osvjetljenjem.
Grijaći jastučić | 3 razine temperature
Šifra LTK760
Funkcija automatskog gašenja i 6 razina odabira temperature grijanja. Grijanje se regulira putem urpavljača sa zaslonom s pozadinskim osvjetljenjem. Automatsko gašenje nakon 90 minuta rada.

Visokotemperaturni grijaći jastučići Rossmax
Šifra Dimenzije
Super udoban i topao jastučić s 4 razine grijanja. Presvlaka nudi luksuznu mekoću i umirujuću udobnost. Presvlaka se lako održava pranjem. Prikaz razine grijanja vidi se na digitalnom LCD zaslonu upravljača.

Električni grijač za stopala s masažerom
Šifra
Pružit će vam ugodne trenutke opuštanja i ublažiti nelagodan osjećaj hladnoće. Dimenzije: 30x30x24 cm; Grijanje: 2 režima odabira temperature; Masaža: 2 režima odabira inteziteta masaže.

Grijač stopala LTK770
Šifra LTK770
Dolazi s funkcijom automatskog isključivanja nakon 90 minuta neprekinutog rada. Mogućnost odabira 3 razine temperaturnog režima rada. Održavanje - podstava grijača za stopala može se prati - prije skidanja podstave potrebno je ukloniti kabel koji se jednostavno uklanja i opet ponovno vraća na mjesto.

Lift fotelja CINNAMON I, bež


3GODINE JAMSTVA
Lift fotelja CINNAMON I presvučena je mekanom chenille tkaninom koja pruža osjećaj topline i udobnosti. Unutarnja ispuna od pjene visoke gustoće osigurava optimalnu potporu i dugotrajnu izdržljivost, dok pažljivo odabrana tvrdoća sjedala jamči stabilnost i udobnost pri svakodnevnoj uporabi. Opremljena je praktičnim bočnim džepom za odlaganje sitnica te upravljačem s integriranim USB priključkom. Zahvaljujući snažnom motoru i nosivosti do 135 kg, prilagođena je različitim potrebama korisnika. Poseban mehanizam omogućuje istovremeno podizanje fotelje, naginjanje naslona i podizanje oslonca za noge, olakšavajući ustajanje i pružajući visoku razinu udobnosti tijekom odmora i opuštanja.
Lift fotelja CINNAMON II, bež


3GODINE JAMSTVA
Lift fotelja CINNAMON II presvučena je mekanom chenille tkaninom koja pruža ugodan osjećaj na dodir i dodatnu udobnost pri sjedenju. Unutarnja ispuna izrađena je od pjene visoke gustoće, s pažljivo uravnoteženom gustoćom i tvrdoćom sjedala, čime se osigurava stabilna potpora i dugotrajna izdržljivost. Za veću praktičnost, fotelja je opremljena bočnim džepom za odlaganje sitnica te jednostavnim upravljačem s integriranim USB priključkom. S nosivošću do 150 kg i pouzdanim motorom, CINNAMON II osigurava siguran i tih rad, dok kotačići s kočnicama omogućuju lakše i sigurnije pomicanje. Napredni sustav pokreta omogućuje istovremeno podizanje fotelje, naginjanje naslona i podizanje oslonca za noge, kao i zasebno podizanje ili spuštanje naslona, pružajući korisniku maksimalnu prilagodljivost i visoku razinu udobnosti tijekom odmora i opuštanja.
Lift fotelja CLOUD I, siva


3GODINE JAMSTVA
Lift fotelja CLOUD I presvučena je mekanom chenille tkaninom koja pruža ugodan osjećaj na dodir i dodatnu udobnost pri sjedenju. Unutarnja ispuna od pjene visoke gustoće, s pažljivo odabranom gustoćom i tvrdoćom sjedala, osigurava stabilnu potporu i dugotrajnu izdržljivost u svakodnevnoj uporabi. Fotelja je opremljena bočnim džepom za odlaganje sitnica te jednostavnim upravljačem s integriranim USB priključkom. S nosivošću do 135 kg i pouzdanim motorom, CLOUD I jamči siguran i tih rad. Napredni sustav pokreta omogućuje istovremeno podizanje fotelje, naginjanje naslona i podizanje oslonca za noge, olakšavajući ustajanje te pružajući visoku razinu udobnosti tijekom odmora i opuštanja.
Lift fotelja CLOUD II, siva


3GODINE JAMSTVA
Lift fotelja CLOUD II presvučena je mekanom chenille tkaninom koja pruža ugodan osjećaj na dodir i dodatnu udobnost pri sjedenju. Unutarnja ispuna od pjene visoke gustoće, s pažljivo uravnoteženom gustoćom i tvrdoćom sjedala, osigurava stabilnu potporu i dugotrajnu izdržljivost. Fotelja je opremljena bočnim džepom za odlaganje sitnica te jednostavnim upravljačem s integriranim USB priključkom. S povećanom nosivošću do 150 kg i pouzdanim motorom, CLOUD II jamči siguran, stabilan i tih rad, dok kotačići s kočnicama omogućuju jednostavno i sigurno pomicanje. Napredni sustav pokreta omogućuje istovremeno podizanje fotelje, naginjanje naslona i podizanje oslonca za noge, kao i zasebno podizanje i spuštanje naslona, pružajući maksimalnu prilagodljivost i iznimnu udobnost tijekom odmora i opuštanja.
















Termofor 2L
Šifra
TF-01
Zapremina 2l, izrađen od gume. Bez navlake, dolazi u crvenoj i plavoj boji. Ovo je nadaleko najpopularniji termofor u Hrvatskoj s više od 100.000 zadovoljnih kupaca u posljednjih desetak godina. Iznimno je izdržljiv i robustan i vrlo rijetko dolazi do bušenja i curenja.

Termofor s navlakom 2L
Šifra
TFN
Termofor ima 2 litre zapremine. Dolazi s ugodnom navlakom od tkanine (navlaka ima jedan uzorak).

Termofor ljubičasti 2L
Šifra
TF-03
Zapremnina: 2l. Dimenzije: 30 (35) x 17 cm. Materijal: PVC. Boja: Ljubičaste boje, tekstura kuglica s obje strane.

Šifra Opis
OC-42603 M | 85-100 cm
OC-42604 L | 100-120 cm
OC-42605 XL | 120-145 cm
Topli pojas za struk napravljen od 100% vunene tkanine. Elastične je strukture. Preporuka ga je koristiti kod liječenja prehlade, naprezanja i bolova mišića u području struka, reumatizma, išijasa, kada je potrebno utopliti područje struka. Pomaže kod opuštanja mišića održavanjem tjelesne temperature. Pogodan je za svakodnevnu upotrebu (dovoljno tanak da se može koristiti ispod odjeće). Vunena tkanina je ugodna za nošenje i omogućava koži da diše za vrijeme nošenja. Lako se održava pranjem u mlakoj vodi.

Električni termofor u obliku srca
Šifra INN-054
Ovaj električni termofor u obliku srca jednostavan je za korištenje. Potrebno ga je priključiti na napajanje od 220V i on će se ugrijati za 15 minuta. Nakon što se termofor ugrijao, potrebno ga je isključiti iz struje.

Termofor zeleni 3L
Šifra
TF-02
Zapremnina: 3l. Dimenzije: 30 (36) x 21,7 cm.
Materijal: PVC. Boja: Zelene boje, tekstura šahovnice s obje strane.

Termofor ružičasti u obliku srca 1L
Šifra
TF-04
Termofor ružičasti u obliku srca 1L. Zapremnina: 1l.
Dimenzije: 19,5 (27) x 21 cm. Materijal: PVC. Boja: ružičasta boja s teksturom srca s obje strane.


NebulFlaem 4.0 inhalator
Šifra TOW017504
Inhalator NebulFlaem 4.0 opremljen je inovativnim RF9 raspršivačem s mogućnošću raspršivanja čestica u četiri veličine. Namijenjen je za kućnu i profesionalnu upotrebu. Kućište NebulFlaema 4.0 izrađeno je od ABS -a pomiješanog s antimikrobnim dodatkom BioCote® koji trajno pruža antibakterijska, antifungalna i antivirusna svojstva.
Tehničke karakteristike:
• Maksimalni tlak: 3,5 ± 0,5 bara (podesivo)
• Protok: približno 14 l/min
• Buka (na 1 m): približno 55 dB (A)
• Rad: Kontinuirano

• Dimenzije: 20x29,5x10 cm
• Težina: 2,1 kg
• Maksimalni kapacitet raspršivača: 8 ml
• Kompatibilan s Rhino Clear® nastavkom
Familino by Flaem inhalator za djecu i odrasle
Šifra TOW009850
Izdržljiv i inovativan inhalator u živoj zelenoj boji opremljen je inovativnim RF8 raspršivačem sa sustavom uštede lijekova i 2 načina raspršivanja. Idealan za kućnu uporabu s ugodnim zvukom za uho i potpunim setom pribora za cijelu obitelj. Veličina čestica je testirana i potvrđena od strane TÜV Rheinland LGA Products GmbH. Ne sadrži ftalate i bisfenol A (BPA).Siguran i hipoalergen.
Tehničke karakteristike:
• Maksimalni tlak: 1.8 ± 0.3 bar
• Protok: približno 9 l/min
• Buka: ≤54dB(A)
• Rad: Kontinuirano

• Dimenzije: 16.8 x 17.2 x 10.7 cm
• Težina: 1,2 kg
• Maksimalni kapacitet raspršivača: 8 ml
Flaem Puppy inhalator za
Šifra TOW021037

Inhalator za brzu i učinkovitu inhalaciju s novim prijateljskim oblikom za djecu. Inhalator Puppy opremljen je RF8 Dual Speed čašicom raspršivača i u potpunosti je izrađen od 100% sigurnih i testiranih materijala. Proizveden je u Italiji, kompatibilan je s Rhino Clear® nazalnim tušem. Uz Puppy inhalator dolaze ‘Soft Touch’ maske za odrasle i djecu.
Tehničke karakteristike:
• Maksimalni tlak: 1,8 ± 0,3 bar
• Protok: Približno 9 l/min
• Buka (na 1 m): Približno 52 dB (A)
• Dimenzije: 17,7(D) x 16(Š) x 13,5(V) cm
Flaem 4NEB inhalator

Kompletan i učinkovit inhalator za ciljane tretmane zahvaljujući inovativnoj RF9 čašici raspršivača s 4 načina raspršivanja. Certificirani Flaem 4Neb inhalator s RF9 raspršivačem i najmanjim MMAD česticama na tržištu. Jak i izdržljiv kompresor omogućava neprekidni rad i karakterizira ga niska razina buke. Brzo i učinkovito raspršivanje svih lijekova dostupnih na tržištu, uključujući one koji se koriste za astmu, alergije, KOPB i sl.
Tehničke karakteristike:
• Maksimalni tlak: 1,8 ± 0,3 bara
• Protok: Približno 9 l/min
• Buka (na 1 m): Približno 55 dB (A)
• Rad: Kontinuirano
• Dimenzije: 15x21x11 cm
• Težina: 1,8 kg
• Maksimalni kapacitet raspršivača: 8 ml
Kompresorski inhalator NELLA by Flaem
Šifra TOW013676 Šifra TOW012986
Terapeutski učinak na cijeli dišni sustav. Inhalator može raditi na dva načina rada: »Standardni« (zatvoreni poklopac) - 0,19 ml/min i MMAD 3,34 μm. »Brzi« (otvoreni poklopac) - 0,32 ml/min i MMAD 3,67 μm

Flaem Rhino Clear Sprint baterijski tuš za nos


Rhino Clear Sprint tuš za nos posebno je dizajniran kao samostalni uređaj za ispiranje sekreta, prašine i štetnih tvari iz nosa te za tretman nosne šupljine lijekovima. Zahvaljujući korištenju baterija, Rhino Clear Sprint irigator potpuno je mobilan i samostalan uređaj. Opremljen je s komorom za raspršivanje koja se može napuniti s maksimalno 15 ml otopine koju Rhino Clear Sprint tuš za nos može u cjelosti raspršiti u 3 minute.
Tuš za nos Flaem Rhino Clear
TOW000627

Flaem Rhino Clear tuš za nos (irigator) - kompatibilan sa svim Flaemovim kompresorskim inhalatorima. Služi za ispiranje sekreta, prašine i štetnih tvari iz nosa te za tretman nosne šupljine lijekovima. Opremljen je s komorom za raspršivanje koja se može napuniti s maksimalno 10 ml otopine koju Rhino Clear tuš za nos može u cjelosti raspršiti u 2 minute.
Flaem LightNeb prijenosni mesh inhalator
Šifra TOW017928
5% PDV
LightNeb inhaltor spada u novu generaciju bešumnih mesh inhalatora. Zahvaljujući svojoj inovativnoj “Vibrating Mesh” tehnologiji, u finu maglicu pretvara čak i lijekove u suspenziji kao što su beklometazon i budezonid (kortikosteroidi), i to čini u potpunoj tišini.

• Maska za bebe veličina 1 (1-11 mjeseci starosti)
• Konektor za masku
TEHNIČKE KARAKTERISTIKE:
Brzina isporuke ml/min ≥ 0,30 MMAD μm 3,7 - 4,6
Dio koji se može udahnuti < 5 µm (FPF) 65%
Maksimalni kapacitet 10 ml



Raspršivači (za dostavu terapije u gornji i donji dišni sustav korisnika)
Svi Flaem kompresorski inhalatori standardno su opremljeni raspršivačima izvanredne efikasnosti i kvalitete, čije su performanse neovisno certificirane i potvrđene TÜV Rheinland certifikatom, kao i neovisnim ispitivanjima
Njemačkog sveučilišta u Mainzu sukladno normi EN13544. Više od 50 godina iskustva u proizvodnji, distribuciji i prodaji inhalatora, te slušanja potreba krajnjih korisnika, utkano je u vrhunske i danas najnaprednije tehnologije



OROFARINGEALNA REGIJA TRAHEOBRONHIJALNA REGIJA


PLUĆNA REGIJA PERIFERNA REGIJA
RF9 raspršivač
Šifra Opis TOW014155 s usnikom TOW017993 bez usnika
1 raspršivač, 4 terapije
Novi Flaem raspršivač opremljen inovativnim selektorom omogućava ciljane terapije za različite dijelove dišnog sustava.
4 načina raspršivanja s RF9



Certificirani raspršivač Flaem RF9 omogućava odabir željene veličine čestica kroz 4 načina rada: Raspršivač postavljen u položaj 0 | čestice veće od 7 μm | za gornje dišne putove (orofaringealna regija) | velika brzina nebulizacije; Raspršivač postavljen u položaj 1 | čestice veće od 5 μm | za traheobronhijalnu regiju; Raspršivač postavljen u položaj 2 | čestice između 3 i 4 μm | za plućnu (bronhijalnu) regiju; Raspršivač postavljen u položaj 3 | čestice između 2 i 3 μm | za perifernu regiju (čestice dolaze do plućnih alveola
rada Flaemovih raspršivača. To uključuje mogućnosti prilagodbe veličine čestica, prilagodljivi sustav rada ventila te sustav za odabir dvije brzine raspršivanja. Dodatno jamstvo kvalitete predstavlja proizvodnja u Italiji, u skladu s najstrožim kontrolama kvalitete i sigurnosnim standardima. Tvrtka Flaem danas predstavlja sinonim za vrhunsku kvalitetu, dugovječnost i izvanredne rezultate u provođenju terapije gornjih i donjih dišnih puteva.


Inovativni pristup kontroli terapije, koji se ostvaruje odabirom jedne od dvije brzine raspršivanja (MIN/MAX) na samoj čašici, omogućava korisniku potpunu kontrolu nad vremenskim trajanjem terapije. Tehnologija dvostruke brzine raspršivanja



Ističe se učinkovitim sustavom za uštedu lijekova i 2 načina raspršivanja čestica. Jednostavan je za sastavljanje, rastavljanje, korištenje i čišćenje. RF8 Basic raspršivač
RF9 set dijelova
Šifra TOW014158

Set dijelova sadrži: raspršivač RF9, usnik, masku Soft Touch za odrasle, masku Soft Touch za djecu, cijev dužine 1 m. Dijelovi iz seta izrađeni su od antialergijskih materijala, bez ftalata i BPA i testirani su u skladu s europskom normom EN 10993-1 “Biološka evaluacija medicinskih proizvoda” te prema Direktivi 93/42/EEZ Europske unije o medicinskim proizvodima.
Flaem RF8 Dual Speed raspršivač za lijek s usnikom
TOW021498

Tehnologija dvostruke brzine raspršivanja s inovativnim pristupom kontroli terapije, koji se ostvaruje odabirom jedne od dvije brzine raspršivanja (MIN/MAX) na samoj čašici. Omogućava korisniku potpunu kontrolu nad vremenskim trajanjem terapije.
Flaem RF8 - Dual Speed, set dijelova
Šifra
TOW021499
NOVAMA Familino RF8EVO set za raspršivanje
Šifra Opis
TOW019009 za djecu
TOW010268 za odrasle

Raspršivač RF8 Evo s dvostupanjskom regulacijom parametara raspršivanja te Drugsaver nastavkom. Elementi koji se najčešće gube izrađeni su od srebrnog materijala kako bi se lako mogli pronaći. Set se sastoji od: Nastavak za usta, crijevo za zrak dužine 2 metra, maska s mekim rubom i ventilom protiv raspršivanja.
Flaem maska za inhalator | Ghibli Plus soft touch
Šifra Opis
TOW005660 za odrasle
TOW005661 za djecu


Ugodna na dodir i lako se prilagođava što čini liječenje još ugodnijim, posebno za osobe koje ne mogu koristiti usnik. Maska Soft Touch je plave boje, ne sadrži štetne tvari poput BPA i ftalata.
Flaem maska za inhalator
Šifra Opis
TOW000631 za odrasle
TOW000632 za djecu
Flaem maska za inhalator
Šifra Opis
TOW017547 za odrasle
TOW017548 za djecu




RF8 - Jet Basic raspršivač za lijek i inhalacijske otopine

Namijenjen za upotrebu s kompresorskim klipnim inhalatorima. Jednostavan raspršivač koji se lako sastavlja, rastavlja, koristi i čisti. Štedi lijek (vrlo niski preostali volumen lijeka/otopine).
RF7 Dual Speed raspršivač za lijek i inhalacijske otopine

Osnovna prednost RF7 Dual Speed raspršivača je mogućnost dvostrukog ubrzanja inhalacije. Poseban ventil raspršivača omogućava isporuku aerosola samo tijekom faze udisanja, zahvaljujući čemu je iskoristivost lijeka veća - ne dolazi do njegova rasipanja. MMAD prema novoj normi EN135441 - MIN 3,78 μm | MAX 4,58 μm.
Flaem maska za inhalator za djecu
Šifra Opis
TOW010243 1-3 godine
TOW010244 1-11 mjeseci
TOW010245 0-1 mjesec


Šifra Opis
TOW000624 cijev dužine 1 m
TOW000596 cijev dužine 2 m
Filter za inhalatore



Filter za inhalatore

la Coccinella.
Inhalator za djecu i odrasle
NA-100 | ROSSMAX

Snažan i izdržljiv kompresorski inhalator namijenjen i djeci i odraslima. Intenzitet inhalacije se podešava na ventilu. Praktični pretinac za masku i crijevo u sklopu samog inhalatora. Tehnologija podešavanja ventila - VAT omogućuje odabir različitih intenziteta protoka u rasponu od 0,15 do 0,35 CC/min. Snažan klipni kompresor (2,96 bara tlaka). Ugrađen nosač raspršivača. Maska za djecu i odrasle.
Tehničke karakteristike:
• Napajanje: AC 230 V/50 Hz ili AC 220 V/60 Hz
• Potrošnja: ≤ 130 W
• Razina buke: ≤ 55 dBA (na udaljenosti od 1 m)
• Raspon pritiska kompresora: ≥ 29 Psi (0,2 MPa)
• Raspon protoka u litrama: ≥ 3,5 litara po minuti
• Raspon temperature pri radu: 50°F - 104° F (10°C - 40°C)
• Raspon vlage pri radu: ≤ 90% RH
• Raspon atmosferskog tlaka pri radu: 800-1060 hPa
• Dimenzije: (dužinaךirina×visina) 280mm×190mm×100mm
• Težina: 1800 g (bez dodataka)
• Kapacitet spremnika za lijek: 5 ml (cm3)
• Veličina čestica: ≤ 2,2 μm (85%)
Profesionalni kompresorski inhalator | ROSSMAX

Šifra HZZO-a: 030306122207
MMAD ≤2.2 μm. Doziranje finih čestica (FPD): 80-85%. Dosljedna veličina finih čestica za djelotvorno liječenje dišnih problema. Patentirana bočica za raspršivač s podesivim ventilom (VAT). Stvara vrlo malo buke pomoću prigušivača i dizajna koji apsorbira vibracije. Precizan dizajn ventilacijskog sustava za intenzivnu uporabu. Moćan klipni kompresor. Usni dio i maske za odrasle i za djecu. Ugrađen držač za inhalacijski set.
Tehničke karakteristike:
• Napajanje: AC 230 V/50 Hz ili AC 220 V/60 Hz
• Potrošnja: ≤ 130 W
• Razina buke: ≤ 55 dBA (na udaljenosti od 1 m)
• Raspon pritiska kompresora: ≥ 29 Psi (0,2 MPa)
• Raspon protoka u litrama: ≥ 3,5 litara po minuti
• Raspon temperature pri radu: 50°F - 104° F (10°C - 40°C)
• Raspon vlage pri radu: ≤ 90% RH
• Raspon atmosferskog tlaka pri radu: 800-1060 hPa
• Dimenzije(dužinaךirina×visina): 222mm×158mm×120mm
• Težina: 1727,5 g (bez dodataka)
• Kapacitet lijeka: 5 ml (kubični centimetar)
Kompresorski inhalator
NE 100 za djecu i odrasle | ROSSMAX
• Prosječna brzina inhalacije: Potpuno otvoren ventil ≥0,4 ml/min (0,9%tna fiziološka otopina); Zatvoren ventil ≥0,15 ml/min Tehničke karakteristike:

Inhalator za djecu i odrasle namijenjen inhalaciji donjih dišnih puteva (pluća). Snažan klipni kompresor. Iznimno jednostavna uporaba. Uključen usnik i maska za odrasle i djecu. MMAD (veličina čestica) <2,6 μm; udio finih čestica (FPD - Fine Particle Dose): 80 - 85%. Ergonomski dizajn. Za kućnu uporabu.
• Napajanje: AC 230 V/50 Hz ili AC 220 V/60 Hz ili AC110V/60Hz
• Potrošnja: ≤ 180 VA
• Razina buke: ≤ 60 dBA (na udaljenosti od 1 m)
• Raspon pritiska kompresora: ≥ 28 Psi (193 kPa)
• Raspon protoka u litrama: ≥ 5,0 litara po minuti
• Raspon temperature pri radu: 10°C – 40°C (50°F - 104° F)
• Raspon vlage pri radu: ≤ 90% RH
• Raspon atmosferskog tlaka pri radu: 700-1060 hPa
• Dimenzije (dužinaךirina×visina): 204,5mm×148mm×108mm
• Težina: 1360 g (bez dodataka)
• Kapacitet spremnika za lijek: 10 ml (cm3)
• Veličina čestica: ≤ 2,6 μm
• Prosječna brzina inhalacije: ≥0,25 ml/min
• Standardna oprema: Komplet za inhalaciju, cijev za zrak, nastavak za usta,filteri (5 kom), maska za odrasle i za djecu
• Veličina čestica: 0,5 do 10 μm (85%)
• Prosječna brzina inhalacije: U potpunosti otvoren ventil ≥ 0,25 ml/min (0,9% fiziološka otopina); Zatvoren ventil ≥ 0,1 ml/min
Kompaktni kompresorski inhalator NL100 za djecu i odrasle | ROSSMAX

MMAD (veličina čestica) ≤ 3.8 μm; udio finih čestica (FPD) 70 - 75 %. Konzistentnost veličine finih čestica za učinkovitu respiratornu terapiju i liječenje dišnih problema. Idealno za djecu i odrasle. Vrlo kompaktan i lagan. Raspršivanje ≥ 0.20 ml/min. Uključen usnik, set za inhalaciju, zračna cijev i filter. Uključena maska za odrasle i maska za djecu.
Tehničke karakteristike:
• Napajanje: AC 230 V/50 Hz ili 220 V/60 Hz ili 110 V/60 Hz
• Potrošnja energije: ≤ 150 VA
• Razina buke: ≤ 67 dBA (na 1 metar udaljenosti od inhalatora)
• Raspon tlaka u kompresoru: ≥ 23 psi (159 kPa)
• Raspon radnog tlaka: ≥ 10,5 psi (72,4 kPa)
• Raspon radnog protoka: ≥ 3,5 lpm
• Raspon radne temperature: od 10 ºC do 40 ºC (od 50 ºF do 104 ºF)
• Raspon vlažnosti pri radu: 10 % ~ 90 % RH
• Raspon atmosferskog tlaka pri radu: 700 – 1060 hPa
• Dimenzije (D x Š x V): 135 x 135 x 100 mm
• Težina: 1049 g (bez dodatne opreme)
• Kapacitet lijeka: približno 6 ml
• Veličina čestica (MMAD): ≤ 3,8 μm
• Standardna oprema: Komplet za inhalator, cijev za zrak, usnik, filtri (5 kom.),maske za odrasle i djecu
Kompaktni
kompresorski inhalator
NL100 za djecu i odrasle | ROSSMAX
Šifra
NI 60
5% PDV
Tehničke karakteristike:
• Napajanje: AC100~240V, 50-60Hz
• Potrošnja struje: ≤ 12W

Šifra HZZO-a: 030306122207
• Razina buke: ≤ 55 dBa (1 metra od uređaja)
• Raspon tlaka u kompresoru: ≥ 16 Psi (110 kPa)
• Raspon radnog tlaka: ≥ 8 Psi (55 kPa)
• Raspon protoka u litrama: ≥ 2,0 lpm
• Raspon radne temperature: od 10°C do 40°C (od 50°F do 104°F)
• Raspon vlažnosti pri radu: ≤ 90% relativne vlažnosti
Inhalator za djecu namijenjen inhalaciji donjih dišnih putova. Intenzitet inhalacije se podešava na ventilu. Različite razine protoka od 0,08 do 0,2 ml/ min. dok veličina čestica ostaje jednaka. Razina buke: ≤ 55 dBa (1m od uređaja). Maska za djecu i nastavak za usta pod kutom.
• Raspon atmosferskog tlaka pri radu: 700-1060 hPa
• Dimenzije (D x Š x V): 215,5mm×134,6mm×93,3mm
• Težina: 334 g (bez dodatne opreme)
• Kapacitet lijeka: 5 ml (kubični centimetar)
• Veličina čestica (MMAD): ≤ 3,0 μm
• Prosječna brzina inhalacije: Potpuno otvoren ventil ≥ 0,2 ml/min< Zatvoren ventil ≥ 0,08 ml/min
• Standardna oprema: komplet za inhalaciju, cijev za zrak, nastavak za usta, filteri (5 kom.), maska za djecu


Rossmax NC200 bešumni inhalator izrađen je najsuvremenijom tehnologijom. Ovaj vrlo tihi i prijenosni ihlator MESH tehnologije koristi električnu energiju za proizvodnju vibracija koje u konačnici stvaraju vrlo fini aerosol od otopine ili lijeka za potrebe liječenja dišnog sustava. Rad na baterije, prijenosni dizajn i vrlo niska razina buke. Proizvodi vrlo fini aerosol koji povećava učinkovitost inhalacije: MMAD (veličina čestica (<4 μm) s dozom finih čestica: 7075% i brzinom raspršivanja od 0,3 ml/min. Inhalator je opremljen funkcijom automatskog isključivanje nakon 10 minuta rada.
Tehničke karakteristike:
• Baterija: 3 V (2* AA alkalne)
• Potrošnja energije: ≤ 1,2 W
• Razina buke: ≤ 20 dBA (na 1 metar udaljenosti od NC200)
• Radna frekvencija: Otprilike 120 kHz
• Raspon radne temperature: od 10 ºC do 40 ºC (od 50 ºF do 104 ºF)
• Raspon vlažnosti pri radu: ≤ 85 % RH
• Raspon atmosferskog tlaka: 700 – 1060 hPa
• Dimenzije (D x Š x V): 42 x 70 x 117 mm
• Težina: 70 g (bez baterija i dodatne opreme)
• Kapacitet lijeka: Najviše 8 ml/cm3
• Veličina čestica (MMAD): ≤ 4,0 μm
• Prosječna stopa nebulizacije: ≥ 0,30 cm3/min pri temp. od 25 °C
• Standardna oprema: Posuda za lijek, usnik, maska za djecu, USB kabel
Čašica za lijek za gornje dišne puteve
Šifra
NB_AC_025_00

Namijenjena je za tretiranje gornjih dišnih puteva, odnosno upotrebu u liječenju rinitisa, sinusitisa, faringitisa, tonzilitisa, laringitisa, traheitisa i traheobronhitisa u čijoj je terapiji potrebno primjeniti lijek u obliku većih čestica. VAT tehnologija: ≥0.15 (zatvorena) / >0.5 ml/min (otvorena) pri konzistentnoj veličini čestica (MMAD) 5-10 μm.
Šifra Opis
NB_AC_003_00 za odrasle
NB_AC_004_00 za djecu

Za inhalatore NB60, NH60, NB80, NA100, NE100, NB500, NC300
Set dijelova za inhalatore
Šifra
NB_AC_025_00
Set dijelova za inhalatore sadrži: N1 čašicu za inhalaciju; Filter za zrak (5 kom.); Crijevo za kompresorske inhalatore (150 cm); Masku za odrasle i za djecu.

Fleksibilno crijevo
Šifra
NB_AC_026_00


Namijenjena je za tretiranje donjih dišnih puteva, odnosno upotrebu u liječenju astme, bronhitisa, bronhiolitisa, bronhiektazije i bronhopneumonije u čijoj je terapiji potrebno primjeniti lijek u obliku sitnih čestica (manjih od 3µm) koje mogu doprijeti do najudaljenih dijelova pluća.VAT tehnologija: od 0,080.50 ml/min pri konzistentnoj veličini čestica (MMAD) ≤ 2.2 μm.
Silikonska maska za inhalatore Čašica za lijek
Silikonska maska za inhalator NC200
Šifra
NB_AC_036_00
Šifra Opis

Za kompresorske inhalatore: NB60, NI60, NB80, NA100, NE100, NB500
NB_AC_005_00 Šifra
MC-06 za NB-02l - 15 kom

CU-02 za NB-07 - 10 kom Šifra
NB_AC_006_00
Šifra
NB_AC_007_00

Filter za zrak Čašica za lijek za donje dišne puteve
Za inhalatore NB80, NB500, NA100 i NE100
Za inhalatore NB60, NI60 i NH60



Dječji nosni aspirator Vitammy COLIBRI
Šifra

Nosni aspirator BRAUN
NBA050EU | ručni
Aspirator Vitammy Colibri uređaj je koji služi za usisavanje sluzi i sprječava progresiju komplikacija. Zastoj sluzi može dovesti do upale sinusa ili donjih dišnih puteva, što može dovesti do pada imuniteta što dobar aspirator čini osnovnim uređajem kućne ljekarne roditelja male djece. Vitammy Colibri može se koristiti kod djece od 0 - 12 godina starosti. Uz dva fleksibilna nastavka, korisnik može lako čistiti djetetov nos bez obzira na širinu djetetovih nosnica ili gustu i rijetku sluz.
Nastavak užeg grla - namijenjen je manjoj djeci i njihovim malim nosićima, kao i za vodenast i rijeđi nosni sekret.
Nastavak šireg grla - namijenjen starijoj djeci i za upotrebu kod gustog sekreta.
Gumica za dječji nosni aspirator COLIBRI

Punjivi električni nosni aspirator
TOW004603 Šifra HNA-100
2 u 1, ručni i automatski način rada. Lako se čisti, medicinski certificiran, vodootporan. Učinkovito usisavanje putem moćnog motora uz manju razinu buke. Jednostavna upotreba.

Mjerač vršnog protoka zraka
Šifra Opis
PF120A za odrasle
PF120C za djecu

Kompaktan, lagan i prenosiv. Ugrađen fleksibilan sustav upravljanja u tri zo ne. Lako čitljive znamenke. Raspon mjerenja: 50 - 800 L/min.


Meke i fleksibilne silikonske maske su udobne i istovremeno dobro prianjaju. Jednostavno rastavljanje i sklapanje kod čišćenja. Proizvod ne sadrži ni lateks ni BPA. Uređaj dolazi u 3 izvedbe: s malom maskom za pacijente do 18 mjeseci, sa srednjom maskom za pacijente od 1 do 5 godina starosti i bez maske za stariju djecu i odrasle. Zapremnina komore: 175 ml.
TOW017494

Ovaj uređaj služi za usisavanje sekreta iz nosića djeteta pomoću sile usisa koju stvara osoba koja koristi uređaj. Uređaj se sastoji od usnika, cijevi i spremnika za sekret. Brzo i nježno čisti začepljene nosnice. Namijenjen za dojenčad i malu djecu. Siguran i higijenski. Kontrolirana snaga aspiracije. Lak za čišćenje: dijelovi perivi u perilici posuđa. Jednokratni i veliki filtri za hvatanje i zadržavanje sluzi. Bez BPA (bisfenola A). 2 nastavka za nos. Futrola za pohranu svih dijelova zajedno. U setu 5 jednokratnih filtara.
HNA-300 aspirator za nos s punjivom baterijom

Aspirator za nos HNA-300 s punjivom baterijom siguran je i higijenski način za ublažavanje i čišćenje začepljenosti nosa. Dolazi s dvije vrste silikonskih vrhova za višekratnu upotrebu. Jednostavan rad - pritisnite i držite gumb za uključivanje a kada ste završili jednostavno otpustite gumb što će isključiti uređaj. Lagano čišćenje - skinite čašicu za skupljanje sluzi i vrh s aspiratora i operite ih u toploj vodi sa blagim sapunom. Punjiv i prenosiv - jednostavno punjenje pomoću USB kabela za punjenje i mala težina čine ga izuzetno prenosivim stoga ćete ga lako ponjeti sa sobom gdje god krenuli.
Mini-Wright profesionalni mjerač vršnog protoka zraka
Šifra Opis
CC-3103387 za odrasle | između 60-880 l/min
CC-3104710 za djecu | između 30-400 l/min


AirZone kućni, džepni mjerač vršnog protoka zraka

Lagan i prijenosan džepni mjerač vršnog protoka zraka prikladan za djecu i odrasle. Raspon mjerenja je od 60 - 800 l/min.
Tjedni organizator lijekova na HRVATSKOM jeziku
Šifra
Odjeljci za pojedine dane mogu se izvaditi. Svaki je pretinac proziranne trebate otvarati pretinac kutijie kako bi provjerili da li ste uzeli lijek. Pretinci za sedam dana u tjednu: jutro, podne, večer i noć.

Organizator lijekova u boji | 7 x 3
Tjedna kutija za tablete na HRVATSKOM jeziku
Pomaže pri pravilnoj raspodjeli tableta i/ili vitamina. Tjednu kutiju za tablete karakterizraju pretinci za više tableta koji se lako otvaraju te su pogodni za osobe starije životne dobi. Na pretincima se nalaze Brailleove oznake za slijepe i slabovidne osobe. Oznake dana na svakom pretincu su na hrvatskom jeziku.



Organizator lijekova u boji | 7 x 2
Planer tableta Ezy Doze za 7 dana, s tri pretinca (za uzimanje tableta tri puta na dan) savršen je za propisane lijekove ili organiziranje vitamina.

Okrugla tjedna kutijica za tablete na engleskom jeziku
Tjedni organizator lijekova »Valjak«
Planer tableta Ezy Doze za 7 dana, s dva pretinca (za uzimanje tableta dva puta na dan) savršen je za propisane lijekove ili organiziranje vitamina.

Stane na dlan i lako se otvara. Brailleove oznake za slijepe i slabovidne osobe. Oznake na engleskom jeziku. Jedan pretinac za svaki dan u tjednu.

Ovalna dnevna kutijica za tablete na hrvatskom jeziku
Sedam raznobojnih pretinaca za organizaciju lijekova i drugih malih predmeta. Moguće je dobiti dva pretinca iz jednog pomoću dodatnog poklopca. Jednostavno otvaranje zakretanjem. Promjer kutijica je 5 cm, a ukupna visina 18,4 cm.

Dnevna kutijica za tablete na HRVATSKOM jeziku
Dnevna kutijica za tablete s 2 pretinca s oznakama doba dana na hrvatskom jeziku.

Džepna četvrtasta kutijica za lijekove
Jednodnevna kutijica za diskretno nošenje lijekova, vitamina i drugih malih predmeta. Zatvarač čvrsto sjeda i onemogućuje slučajno otvaranje kutijice.



Idealna prilikom uzimanja lijekova ili vitamina četiri puta dnevno u određenom dijelu dana - jutro, podne, večer i noć. Pretinci se lako otvaraju što ih čini odličnima za osobe starije životne dobi. Svaki pretinac je dovoljno velik za nekoliko tableta.

Kutijica za tablete privjesak za ključeve
U elegantnoj srebrnoj boji. Prikladan za držanje aspirina, vitamina i tableta protiv prehlade. Hermetički zatvarač drži tablete na suhom.

Okrugla dekorativna kutijica za tablete
Šifra 67409
Diskretan način za nošenje tableta sa zanimljivim i modernim uzorcima. Kompaktne kutijice za tablete imaju tri odjeljka te ukupan kapacitet 10 -12 tableta. Prikladno za kraća putovanja ili nošenje tableta kroz dan. Poklopac kutijice se otvara pritiskom na gumb.


Žlica za doziranje
Kapacitet: 10 ml. Lako očita vanje doze. Nelomljiva. Dvije žlice za doziranje. 10 ml. La ko očitavanje doze. Nelomlji ve. Četka za čišćenje.


Pumpica za nos
Pumpica (aspirator) za djecu i odrasle. Uklanja sekret iz nosa.

Rezač tableta sa spremnikom Rezač i usitnjivač tableta
Šifra 67767
Rezač tableta sa spremnikom Čelična oštrica. Periv u stroju za suđe. Komadići tablete ne ispadaju pri rezanju.


Usitnjivač tableta Ezy crush L
Usitnjivač tableta »Ezy Crush« L. Jednostavno usitnjava tablete. Velik, ergonomski oblikovan poklopac sa spremnikom za tablete. Pretinac za usitnjene tablete je proziran, tako da možete vidjeti postupak usitnjavanja. Širina: 7,5 cm.


Šprica i žličica za davanje lijeka

Žličica i šprica imaju volumen od 10 ml. Oznake na šprici lako su čitljive. Precizna šprica isporučuje se s plastičnom cijevi koja se može ukloniti radi lakšeg punjenja te je dizajnirana za laku primjenu lijeka.


Šifra 67750
Rezač i usitnjivač tableta. Rezač s dodatnom kutijicom za tablete. Mali mlinac za pretvaranje tableta u prah za lakše gutanje.



Usitnjivač tableta sa spremnikom (PC-12)
Trodijelni uređaj za raspršivanje tableta bez napora drobi tablete u prah radi lakšeg gutanja. Spremnik za tablete ugrađen je u drobilicu za pohranu vaših lijekova. Gornji dio se također može koristiti kao šalica za piće.



Kapaljka za doziranje, plastična, 1 kom
Kapaljka za doziranje. Zapremnina kapaljke: 5 ml. Lako se rastavlja i čisti.

Nježno čisti sluz iz bebinog nosa. Za višekratnu upotrebu.


Hardverska i softverska rješenja omogućuju starijim osobama i osobama s fizičkim invaliditetom kvalitetniju i napose sigurniju razinu života bilo da žive samostalno u vlastitom domu ili se nalaze u domu.
Kombinacija ručnog odašiljača ili, po želji, dodatno opremljenog odašiljača u obliku ogrlice, može se koristiti kao sustav za poziv njegovatelju. Bežično zvono za utičnicu omogućuje optičku i akustičku signalizaciju. Pritiskom na gumb pacijent može signalizirati njegovatelju ili članovima obitelji da mu je potrebna pomoć.
Setovi za poziv njegovatelju „EASYWAVE“ s odašiljačem za ručni zglob
• 80 000 Easywave-Set - osnovni Easywave set za poziv njegovatelju.
• 80 010 Easywave-Set „PLUS“ s funkcijom potvrde - uključuje funkciju potvrde i dolazi s odašiljačem za ručni zglob.
Ponavljač signala za utičnicu „EASYWAVE“
• 80 040 Ponavljač signala za utičnicu „EASYWAVE“
Dodatni odašiljač „EASYWAVE“
• 80 030 Odašiljač za ručni zglob, pojedinačno - samostalni odašiljač koji se nosi na ručnom zglobu.
• 80 031 Odašiljač za vrat, pojedinačno - samostalni odašiljač u obliku ogrlice.
• 80 032 Ručni odašiljač, pojedinačno, s velikom, signalno obojenom tipkom za aktivaciju - odašiljač s velikom, jasno vidljivom tipkom za jednostavno korištenje.



TeleAlarm
Proizvodi i Usluge
TeleAlarm nudi širok asortiman proizvoda koji su međusobno usklađeni kako bi osigurali optimalnu funkcionalnost i lakoću korištenja. Tim stručnjaka TeleAlarma posjeduje bogato znanje i iskustvo te pruža vrhunske savjete i profesionalnu instalaciju opreme.
Ponuda uređaja i usluga tvrtke TeleAsist uključuje:
• Carephones specijalizirane uređaje za asistivnu tehnologiju
• Mobilne sustave za hitne pozive
• Rješenja i dodatke za NurseCall sustave
Kod izvedbe s funkcijom potvrde, zvučni signal se ponavlja sve dok ne dođe do potvrde pritiskom na tipku na uređaju za poziv (ili na zasebnom odašiljaču). Na raspolaganju je 12 melodija za zvučni signal, svaka u tri razine glasnoće, uz mogućnost kombinacije s ugrađenim LED svjetlosnim signalom. Domet uređaja doseže do 150 metara.
Aktiviranjem odašiljača za ručni zglob ili ogrlicu, telefon se uključuje i automatski poziva do tri unaprijed programirana broja za hitne pozive. Podizanjem slušalice ili pritiskom na tipku „0“ na uređaju omogućuje se razgovor putem ugrađene funkcije za hands-free komunikaciju.
• 80 210 Fon Alarm „EASYWAVE“ - Model telefona za hitne pozive s podrškom za Easywave sustav.
• Pomoću odašiljača Easywave moguće je jednim pritiskom na gumb poslati signal telefonu „Easywave Fon Alarm“, koji zatim automatski poziva tri unaprijed programirana broja.
• Ako primatelj poziva pritisne tipku „0“, omogućuje se razgovor putem ugrađene funkcije za hands-free komunikaciju.
• Ovaj telefon idealan je za omogućavanje osobama kojima je potrebna skrb da u „hitnim situacijama“ zatraže pomoć.
• Uz funkciju hitnog poziva, telefon Easywave može se koristiti i kao standardni telefon s velikim tipkama, što ga čini jednostavnim za upotrebu.






Šifra
DUR-9001
Cijena za osnovni model:
| 1 vanjski džep.

Slika je informativna. Torba dolazi bez sadržaja.

Izvanredna liječnička torba elegantnog dizajna visoke klase. Sofisticirani sustav brave i okvira jamči odlično rukovanje i optimalno korištenje prostora. Izrađena od vrhunske kvalitete, prave kože. Veliki unutarnji pretinac i stabilan aluminijski okvir. S velikim vanjskim džepom na patentni zatvarač, dostupan i s drugim vanjskim džepom na čičak. Dvostruki sustav zaključavanja izrađen od ABS polimera. Ergonomska dvostruka ručka. Dostupna u dvije veličine, po izboru s remenom za rame.
Dimenzije:
• Mala: (DxŠxV) 38x21x27 cm
1 vanjski džep
2 vanjska džepa
• Velika: (DxŠxV) 43x21x27 cm
1 vanjski džep
2 vanjska džepa
RUSTICANA | SPECIAL EDITION
Šifra DUR-7006

Moderne boje susreću se s klasičnim dizajnom: naše posebno izdanje nudi svjež izgled uz uobičajenu kvalitetu. Izrađen od vrhunske kvalitete, prave kože. Veliki unutarnji pretinac i stabilan aluminijski okvir. S velikim vanjskim džepom na patentni zatvarač, dostupan i s drugim vanjskim džepom na čičak. Dvostruki sustav zaključavanja izrađen od ABS polimera. Ergonomska dvostruka ručka. Opcionalno s remenom za rame.
Dimenzije:
• Velika: (DxŠxV) 43x21x27 cm | 2 vanjska džepa
Šifra DUR-9061
Cijena za osnovni model: Mala | 1 vanjski džep.

Posebna završna obrada od najlonske tkanine čini ovu RUSTICANA liječničku torbu posebno laganom i robusnom. Izrađen od izdržljivog najlona Veliki unutarnji pretinac i stabilan aluminijski okvir. S velikim vanjskim džepom na patentni zatvarač, dostupan i s drugim vanjskim džepom na čičak. Dvostruki sustav zaključavanja izrađen od ABS polimera. Ergonomska dvostruka ručka. Dostupan u dvije veličine, po izboru s remenom za rame.
Dimenzije:
• Mala: (DxŠxV) 38x21x27 cm
1 vanjski džep
2 vanjska džepa
RUSTICANA | LIGHT za medicinske sestre
Šifra DUR-9071
Cijena za osnovni model: Mala | 1 vanjski džep.
• Velika: (DxŠxV) 43x21x27 cm
1 vanjski džep
2 vanjska džepa

Robusna torba od najlonske tkanine koja se može prati. Za svakodnevnu upotrebu. Izrađena od izdržljivog najlona. Prednji džep s patentnim zatvaračem. Dodatno: remen za rame. Dvostruki sustav zaključavanja izrađen od ABS polimera. Ergonomska dvostruka ručka.
Dimenzije:
• Mala: (DxŠxV) 38x21x27 cm
1 vanjski džep
2 vanjska džepa
RUSTICANA | LIGHT produžena
Šifra DUR-9181
za osnovni model:
| 1 vanjski džep.
• Velika: (DxŠxV) 43x21x27 cm
1 vanjski džep
2 vanjska džepa

Izdužena i lagana najlonska tkanina čini ovu varijantu Rusticane impresivnom zbog svoje male težine i iznimno duge duljine - 56 cm. Prednji džep na čičak. Dodatno: remen za rame. Dvostruki sustav zaključavanja izrađen od ABS polimera. Ergonomska dvostruka ručka. Dimenzije: (DxŠxV) 58x24x27 cm
Šifra Boja
09.0.5368.00 crvena
09.0.5369.00 zelena
Izrađena od vrhunske kvalitete, prave kože. Sofisticirana izrada šivanja. Veliki unutarnji pretinac i stabilan aluminijski okvir. S velikim vanjskim džepom na patentni zatvarač, dostupan i s drugim vanjskim džepom na čičak. Dvostruki sustav zaključavanja izrađen od ABS polimera. Ergonomska dvostruka ručka.
Dimenzije:
• Velika: (DxŠxV) 43x21x 27 cm
1 vanjski džep
2 vanjska džepa

Šifra

Liječnička torba za ljubitelje klasičnog country doctor stila Tradicionalni izgled s modernom tehnologijom. Klasična liječnička torba od vrhunske kože. Sofisticirana izrada šivanja. Vanjski džep s patentnim zatvaračem. Opcionalno s remenom za rame. Dimezije: (DxŠxV) 37x20x19 cm.


Praktična liječnička torba na rame od mekane nappa kože nudi obilje prostora za medicinsku opremu i materijale. Veliki vanjski džep s patentnim zatvaračem s više manjih džepova. Bočni džep za mobilni telefon. 2 odvojena pretinca s patentnim zatvaračem na stražnjoj strani. Dimenzije: (DxŠxV) 40x20x33 cm.


Umjetna koža.
za osnovni model: Mala

Ovaj vrlo izdržljivi liječnički kofer, izrađen od otporne, ali vrlo lagane ABS plastike, pruža dovoljno mjesta, udobnost i fleksibilnost čak i kad u njemu nosite mnogo stvari. Čvrsta ABS plastika uz dodatke od umjetne ili prave kože pruža iznimnu stabilnost. Veliki unutrašnji prostor, dobra preglednost. Pri otvaranju gornji se pretinci razdvajaju, tako da je sav sadržaj odmah dostupan. Dvostruki mehanizam za zatvaranje od ABS plastike. Ergonomski dizajnirana dvostruka ručka.
Dimenzije:
• Mala: (DxŠxV) 44x24x22 cm
• Velika: (DxŠxV) 44x24x29 cm
Praktično rješenje za mobilni liječnički kofer: čvrsti kofer može se u tren oka pretvoriti u kolica ili torbu na rame i nikada ne gubi svoju klasičnu eleganciju. Izrađena od mekane nappa kože. Prednji džep s patentnim zatvaračem i s preklopom. Uključena naramenica. Dimenzije: (DxŠxV) 47x16x38 cm.


Liječnički kofer s praktičnim vanjskim bočnim džepom s prostorom za DIN A4 dokumente ili bilježnicu. Izrađena od umjetne ili prave kože s okvirom od aluminijskog profila. Ergonomski oblikovana dvostruka ručka. Dvostruki sustav zaključavanja od ABS plastike. Dimezije: (DxŠxV) 43x16x33 cm.

Čvrsto kućište izrađeno od robusnog ABS polimera od aluminijskog profila, nudi najbolju zaštitu za sadržaj čak i u najtežim uvjetima. Kao liječnički kofer, uvjerava svojom fleksibilnom podjelom odjeljaka. Dvostruki sustav zaključavanja izrađen od ABS polimera. Ergonomski oblikovana dvostruka ručka. Dimenzije: (DxŠxV) 43x13x33 cm.

Bollmann | Torba za kućnu njegu
CARE CASE
Šifra Boja
BO 1.04.411 crna
BO 1.04 .415 plava
BO 1.04.417 crvena

Prostrana torba od poliestera s odjeljkom za ključeve različitih pacijenata. Jednostavno prednje otvaranje - prednja strana se u potpunosti otvara i omogućava lagani pristup unutrašnjosti. Dva bočna džepa za uređaje poput mobitela i punjača. Podesiva naramenica i ručka. Prekriveni pretinac za čuvanje ključeva. Prozirni džepić za dokumente. Odvojiva plastična pregrada. Veoma prostrana. Elastične trake za držanje instrumenata. Materijal: Poliester. Dimenzije: 43 cm x 26 cm x 31 cm.
Bollmann | Torba za liječnike ALTERNATIVE
Šifra Boja | Opis
BO 1.05.411 crna | bez naramenica
BO 1.05.417 crvena | bez naramenica
BO 1.05.421 crna | s naramenicama
BO 1.05.425 plava | s naramenicama
BO 1.05.427 crvena | s naramenicama

Poliester. Dimenzije: 40×36×24cm. Ampularij za 46 ampula Duboki središnji odjeljak. Četiri manja varijabilna odjeljka. Dva velika vanjska džepa. Dodatni prozirni unutarnji džep za papire. Odvojive, opcionalne, podstavljene naramenice. Dvije odvojive posude za ampule.
za liječnike
Šifra Opis
09.0.0606.00 crna | skaj
09.0.1705.00 bordo | koža izvana, unutra skaj
09.0.0032.00 crna | koža izvana, unutra skaj
Klasična torba cilindričnog oblika. Dimenzije: 42


Bollmann | Torba za liječnike MEDICARE XL
Šifra Boja
BO 1.01.421 crna
BO 1.01.425 plava
BO 1.01.427 crvena
Veoma lagana i prostrana torba s naramenicom, prikladna za sve medicinske profesionalce. Podesivi plastični odjeljci. Poklopac s elastičnim trakama za instrumente. Dodatni unutarnji džep za dokumente. Inovativni patentni zatvarač. Dno otporno na vodu i prljavštinu. Torba Medicare XL napravljena je od čvrstog spužvastog poliestera. Dimenzije: 46×33×17 cm. Torba je opremljena s tri umetka od pjene za 60 ampula i prozirnom pregradom s magnetskim zatvaračem. Druga strana opremljena je s četiri odstranjiva prozirna okvira za držanje s čičkom. Obje strane ojačane ABS plastikom.
Torba za liječnike PEARL
Šifra Boja
09.0.2139.00 bordo
09.0.2947.00 plava


Klasična liječnička torba cilindričnog oblika, izrađena od najlona, s kožnim aplikacijama. Veliki vanjski džep. Estetski dizajn. Dimenzije: 42 × 22 × 24 cm.
Torba za liječnike COGNAC
VPC (€)

Klasična torba za liječnika boje konjaka, izrađena od fine kože. Dva pretinca, podesivi džepovi za ampule, posjetnice i olovke. Dimenzije: 43 × 18 × 24 cm.
Torba za liječnike / veterinare GIANT
Šifra Boja
09.0.4988.00 konjak
09.0.4990.00 crna

Veliki pretinac i unutrašnji džep. Držač za ampule. Pretinac za posjetnice i olovke. Dimenzije: 41 × 27 × 23 cm.
Torba lječničke BUFFALO STRAP
09.0.4043.00
Klasična liječnička torba od bivolje kože. Cilindrični oblik torbe. Boja: prirodna bež. S trakom za nošenje preko ramena. Prostrana s velikim džepom. Dimenzije: 43 × 21 × 18 cm.

Torba za medicinske sestre PILOT
Šifra Opis
09.0.0036.00 crna | skaj | 35 × 23 × 17 cm
09.0.0354.00 crna | skaj | 44 × 28 × 20 cm
09.0.0436.00 crna | koža | 44 × 28 × 20 cm
Torbe su kožne ili su imitacija kože. Dolaze u dvije veličine, te su crne boje.

Dürasol | Ampularij za 30 ampula
Šifra
09.0.1246.00
Praktičan dozator za ampule nudi prostor za 30 ampula. Otvaranje pritiskom na gumb. Čvrsti držači za ampule različitih veličina (do 22 mm promjera i 105 mm duljine). Prozirni poklopac za bolji pregled. Dimenzije: 20×12×2,9 cm.

Dürasol | Etui za recepte
Šifra DUR-3000

Etui za recepte s elegantnim kožnim džepovima. 9 pojedinačnih pretinaca, držač za olovke. Dimenzije: 18,5x2x24,5 cm.
Torbe za medicinske sestre SPORTY
Šifra Boja
09.0.0645.00 crna
09.0.3003.00 plava
Torba s odvojivom naramenicom i ručkom, unutrašnji pretinci s patentnim zatvaračem, dva vanjska pretinca. Dimenzije: 34 × 26 × 16 cm.

Bollmann | Ampularij za 60 ampula
Šifra Opis
BO 3.07.111 koža | crna
BO 3.07.112 koža | smeđa

Može držati 34 (1-2 cc) + 26 ampula (5-10 cc). Zip zatvarač. Dimenzije> 22 x 16 x 4 cm.
Bollmann | Etui za recepte
Šifra Opis
BO 6.02.411 crna | 20 x 25 cm
BO 6.02.415 plava | 20 x 25 cm
BO 6.02.421 crna | 33 x 26 cm
BO 6.02.425 plava | 33 x 26 cm

Sadrži 11 pretinaca, dolazi uz blok za pisanje i kemijsku olovku. Izrađen od kvalitetnog spužvastog poliestera.
Prijenosna torba za inzulin
Šifra Opis
27254-GIM mala | 17x11,5x5,5 cm
27255-GIM velika | 24x18x6 cm
Termalna torba posebno dizajnirana za nošenje lijekova koji se moraju čuvati na niskim temperaturama, idealna za dijabetičare. Vanjski materijal je vodootporni vinil najlon s pjenastom podlogom. Veličina: .



Podstava: prozračna, antialergijska mikrofibra. Hrvatski proizvod.
Šifra Opis
2041s skaj 2041k koža
Dostupne veličine: 36 - 40

Šifra Opis 2009s skaj 2009k koža

Šifra
Dostupne veličine: 36 - 40

Šifra Opis 2016s skaj 2016k koža
Dostupne veličine: 36 - 44

Šifra Opis
50431s skaj 50431k koža
Dostupne veličine: 36 - 42

Šifra Opis
50434s skaj 50434k koža

Šifra Opis 2014s skaj 2014k koža

Šifra Opis 2040s skaj 2040k koža

Šifra
Šifra Opis 2025s skaj 2025k koža

Šifra Opis


Šifra Opis 2035s skaj 2035k koža

Šifra Opis
5011s skaj 5011k koža
veličine: 36 - 42

Šifra Opis
50101s skaj 50101k koža


Šifra Opis 50489s skaj 50489k koža

Šifra Opis 50450s skaj 50450k koža

Šifra Opis 2015s skaj 2015k koža

Šifra Opis 2026s skaj 2026k koža



Šifra Opis 50131s skaj 50131k koža

Šifra Opis 50420s skaj 50420k koža

Šifra Opis
2023s skaj 2023k koža


Laerdal Medical predstavlja redizajniranu generaciju Little Anne QCPR lutaka za učenje oživljavanja i defibrilacije pomoću korištenja modernih tehnologija kojima smo svakodnevno okruženi s ciljem poticanja masovnije edukacije i učenja kako spasiti život. Pomoću bluetooth pametne tehnologije, povezuje se s tabletima i pametnim telefonima te pruža povratne informacije o kompresijama i ventilaciji putem besplatne apli-

Šifra Opis
137-01350 1 komad
135-01350 6 komada
Redizajnirana generacija Little Anne QCPR lutke za učenje oživljavanja i defibrilacije. Model koji simulira glavu, vrat i torzo odrasle osobe, dizajnirana je za relistični trening BLS vještina, primarno kardiopulmonalnu reanimaciju (KPR) s jasno vidljivim orijentacijskim točkama na glavi, vratu i prsnom košu.
Specifikacije:
• Spol, dob, veličina: Ženski; Torzo; Odrasla osoba
• Značajke dišnih putova: Realno odizanje i spuštanje prsa; Podizanje čeljusti (pomična čeljust); Dišni put ostaje zatvoren kada je vrat nedovoljno ekstendiran; Otvorene nosnice
• KPR značajke: Anatomski orijentiri; Povratne informacije o kompresijama uz pomoć kliker uređaja; Mjerenje
kacije QCPR. Nove Little Anne QCPR lutke proizvedene su od recikliranog materijala radi poboljšane održivosti i smanjenog utjecaja CO2. Čak i uz lakšu građu, Little Anne zadovoljava Laerdalove visoke standarde izdržljivosti, a novi dizajn lutke osmišljen je da bude prilagodljiv i nadogradiv za potrebe sutrašnjice.



kompresija i povratne informacije; Ventilacija usta na usta; Mjerenje ventilacije i povratne informacije; Kompresija prsnog koša; Zabacivanje glave/podizanja čeljusti; Ventilacija s vidljivim odizanjem prsnog koša; Ventilacija putem maske s ventilom
• Administracija simulacije: SkillGuide povezivanje; Povezivanje mobilnih aplikacija; Bluetooth Low Energy (BLE) rad
Obitelj “Little Family QCPR” za učenje oživljavanja
Komplet sadrži:
• Robna marka: Laerdal
• Model: Svjetla koža, Tamna koža, Svjetla+Tamna koža
• Pakiranje: 1kom, 6 kom
• Sadržaj pakiranja (1kom):
Little Anne QCPR lutka (1), Lice lutke (1), Filtri za lutku (11), AA baterije (2), Maramice za lutku (4), Korisnički priručnik (1)
• Sadržaj pakiranja (6kom):
Little Anne QCPR lutka (6), Kofer na kotačićima (1), Lice lutke (6), Filtri za lutku (60), AA baterije (12), Maramice za lutku (24), Korisnički priručnik (1)
Komplet Little Family QCPR sastoji se od realističnih BLS modela koji osiguravaju alternativu i pristupačnu alternativu za KRP trening program.
Modeli koji simuliraju glavu, vrat i torzo odrasle osobe i djeteta dizajnirane su za realistični trening BLS vještina, dok je mode dojenčadi namijenjen za vježbu oživljavanja i odstranjivanje stranog tijela.
Komplet sadrži:
• Robna marka: Laerdal
• Model: Svjetla koža, Tamna koža
• Sadržaj pakiranja: 1x Lutka »Little Anne QCPR« + (1x rezervno lice, 2x rezervna dišna puta, 6x maramica za održavanje, 2x AA baterije); 1x Lutka »Little Junior QCPR« + (1x rezervno lice, 2x rezervna dišna puta, 6x maramica za održavanje, 2x AA baterije); 1x Lutka »Little Baby QCPR« + (1x rezervno lice, 7x rezervnih dišnih puteva, 6x maramica za održavanje, 2x AA baterije); 3x Podloge za trening; 1x Torba za transport s kotačima

Lutka „Little Junior QCPR“ za vježbu oživljavanja
Lutka Little Junior QCPR je razvijena kako bi osigurala pristupačnu alternativu za KPR trening program. Model koji simulira glavu i torzo 5-godišnjeg djeteta, dizajnirana je za relistični trening BLS vještina, primarno kardiopulmonalnu reanimaciju (KPR). Model koji simulira glavu i torzo 5-godišnjeg djeteta, dizajnirana je za relistični trening BLS vještina, primarno kardiopulmonalnu reanimaciju (KPR). Pomoću bluetooth pametne tehnologije, povezuje se s tabletima i pametnim telefonima za pružanje QCPR mjerenja i povratnih informacija.

Komplet sadrži:
• Robna marka: Laerdal
• Model: Svjetla koža, Tamna koža
• Sadržaj pakiranja (1 kom):
1x Little Junior QCPR lutka, 2x rezervna lica, 2x rezervna dišna puta, 6x maramice za održavanje lutke, 1x jakna za lutku, 1x mekana torba za
Lutka “Little Baby QCPR” za vježbu oživljavanja

transport koja služi i kao podloga za trening
• Sadržaj pakiranja (4 kom): 4x Little Junior QCPR lutka, 4x rezervna lica, 4x rezervna dišna puta, 24x maramice za održavanje lutke, 4x jakna za lutku, 1x mekana torba za transport
Lutka Little Baby QCPR je realistična i pristupačna BLS lutka za pedijatriju s objektivnim povratnim informacijama. Pomoću bluetooth pametne tehnologije, povezuje se s tabletima i pametnim telefonima za pružanje KPR mjerenja i povratnih informacija. Pomoću bluetooth pametne tehnologije, povezuje se s tabletima i pametnim telefonima za pružanje QCPR mjerenja i povratnih informacija.
Torzo za vježbu oživljavanja
„Mini Anne Plus“
Brzi način podučavanja. Koristite Mini Anne Plus u više od 600 treninga Ugrađeni kliker omogućuje učenicima da čuju kada je postignuta ispravna dubina kompresije, u skladu s međunarodnim smjernicama za KPR.
Digitalni QCPR uređaj za praćenje uspješnosti oživljavanja
SkillGuide za QCPR lutke povećava vašu sposobnost za mjerenje, praćenje i poboljšanje vaših CPR vještina. Kompatibilan je s Resusci Anne QCPR, Resusci Baby QCPR i Little Anne QCPR.


Sadrži:
• Robna marka: Laerdal
• Model: Svjetla koža, Tamna koža
• Sadržaj pakiranja: 1 kom, 4 kom


Komplet „Mini Anne“ torzo za vježbu oživljavanja (komplet 10 kom)

folija za umjetno disanje (6 rola/36 folija) Prsluk za vježbu Heimlichovog zahvata
Ova zaštitna folija za umjetno disanje koristi se za sudionike tečajeva prve pomoći radi zaštite od infekcije i održavanja osobne higijene.

Prsluk za vježbu Heimlichovog zahvata omogućava realistično vježbanje i simuliranje primjene tehnike Heimlichovog zahvata.


PRIMEDIC HeartSave PAD Trainer
Šifra
07.1.5716.00 Šifra SVT-B0959
Uređaj za edukaciju defibrilacije. Primedic HeartSave PAD ima odlične specifikacije te dolazi s prigodnom tipkom za lakši prijelaz na način rada prilagođen za dječje pacijente. Uređaj je veoma izdržljiv, njemačke izrade, te je njime veoma lako upravljati. Sve funkcije uređaja su jasno naznačene na njegovom prednjem dijelu. Uključeno uz uređaj: Baterija radnog vijeka 3 godine. Elektrode. Podatkovna kartica i program za pohranjivanje i čitanje EKG podataka. AED protokolna lista. Komplet za hitnu pomoć: škare za rezanje odjeće, britvica, sterilne maramice, zaštitne maramice, maska za reanimaciju.


Ovaj AED Trainer prati operacije od 1-2-3 koraka Saver One defibrilatora, čineći ga jednostavnim za korištenje Vodi osobe koje odgovaraju glasovnim uputama na raznim jezicima, od analize EKG-a do šoka i CPR-a. Dolazi unaprijed konfiguriran s 10 realističnih scenarija spašavanja plus 4 potpuno prilagodljiva scenarija koja se mogu odabrati putem bežičnog daljinskog upravljača. Infracrveni daljinski upravljač omogućuje jednostavno pretraživanje i pauziranje scenarija, dajući vam potpunu kontrolu nad vašim treninzima. SAVER ONE T AED Trainer uključuje 2 para podloga za vježbanje, kabel za podloge za vježbanje, daljinski upravljač i najlonsku torbu za nošenje. Podloge za vježbanje služe samo za vježbanje i moraju se spojiti na namjenski spojni kabel za SMART SIMULATOR S1. Ako tražite sveobuhvatno rješenje za svoje potrebe za AED obukom, ne tražite dalje od SAVER ONE T T AED Trainer tvrtke A.M.I. Italia S.r.l. Sa svojim prilagodljivim scenarijima, dugim trajanjem baterije i sveobuhvatnim paketom, ovaj je uređaj ultimativno rješenje za obuku.
Šifra Opis
12.0.4991.00 Kostur
12.0.4992.00 Mišići
12.0.4993.00 Krvne žile
12.0.4994.00 Živci
12.0.5011.00 Koža
12.0.5754.00 Mozak
12.0.5755.00 Kralježnica
12.0.5756.00 Parkins
12.0.5757.00 Lubanja


Na latinskom i engleskom jeziku. Izrađeni na tehničkom papiru. Dimenzije: 50 × 70 cm.

Piramida prehrane
12.0.5864.00
Komplet piramide prehrane se sastoji od 5 tanjura, stalka s policama i setom od 42 vrste hrane uključujući žitarice, bjelančevine, voće i povrće.

Klasični model ljudske lubanje
Šifra Opis
12.0.4443.00 Jednodijelni
12.0.1621.00 Trodijelni
12.0.5444.00 Trodijelni
Klasični model lubanje najbolji je izbor za učenje anatomije. Dimenzije: 20 × 13,5 × 15,5 cm. Težina: 0,7 kg. Vrlo točan prikaz. Može se rastaviti: gornji dio lubanje, bazu lubanje i donju čeljusti. Svaki zub je zaseban.



Modeli ljudske lubanje

U ovoj didaktičkoj verziji sve kosti i parovi kostiju su u boji kako bi se lakše identificirali. Kosti izrađene od 3B BONElike™ materijala izgledaju stvarno, imaju prirodan izgled i gotovo identičnu težinu prirodnih kostiju.

Modeli ljudskog kostura BONElike™ model kralježnice
Visina 85 cm. Težina: 1,5 kg.
Standardni Oscar | Klasični model, muški, idealan za bolnicu, školu, fakultet i laboratorij. Visina: 178 cm.
Standardni A10 | Najprodavaniji model na svjetu! Visina 176.5 cm. Trodjelna lubanja. Individalni postavljeni zubi. Lako odvojivi udovi.
Pomični model kuka Šifra Opis 12.0.4072.00

Faze prolapsa diska i degeneracije kralježaka


Serija anatomskih modela različitih stadija trudnoće
Na prijenosnom stalku. Visina 22 cm. Težina: 0,5 kg.

Dolazi na prijenosnom stalku.
Dimenzije: 17 x 12 x 33 cm.
Težina: 0,55 kg

Modeli zgloba koljena
Dimenyije: 12 x 12 x 34 cm.
Težina: 0,4 kg
5 modela najvažnijih stadija razvoja embrija ili fetusa na prijenosnom stalku. Dim.: 13 × 41 × 31 cm. Težina: 2,1 kg.

Pet puta uvećan u odnosu na prirodnu veličinu.
Dimenzije: 9 × 9 × 15 cm. Težina: 0,1 kg.
Anatomski model oka, 6 dijelova Naljepnica za vozila

Dimenzije: 12 x 12 x h 31 cm.
Težina: 0,44 kg


Model stomatološke njege, 3 puta uvećan
Stopalo s ligamentima
Dimenzije: 18 × 23 × 12 cm.
Težina: 1,5 kg.

Fleksibilna montaža na stabilno postolje. Težina: 1 kg

Modeli ramenog zgloba
Dimenzije: 12x16x22 cm.
Težina: 1 kg
14.0.4071.00 Za unutarnju stranu stakla, 10 × 10 cm
14.0.4070.00 Za vanjsku stranu stakla, 10 × 10 cm



Dimenzije: 16 x 12 x 20 cm.
Težina: 0,35 kg

Dimenzije: 29 x 12 x h 12 cm.
Težina: 0,56 kg

Anatomski model mozga, 4 dijela

Dimenzije: 14 × 14 × 17,5 cm. Težina: 0,9 kg
Anatomski model srca, dvodijelni
Dimenzije: 19 × 12 × 12 cm.
Težina: 0,3 kg

Anatomski model jetre i žučnog mjehura
Dimenzije: 22,5 × 26 × 18,5 cm.
Težina: 1,3 kg

Anatomski model testisa
Dimenzije: 22,5 × 26 × 18,5 cm.
Težina: 1,3 kg

Model grudi s benignim tumorom

Dimenzije: 25,4 x 17,8 x 17,8 cm.
Težina: 0,80 kg.

1. OP ĆI UVJETI
Put u zdravu budućnost www.kvantum-tim.hr
1.1 U pravilu, prodaja se temelji na obostrano potpisanom ugovoru između Kupca i Prodavatelja.
1.2 Profesionalni medicinski proizvodi iz ovog kataloga mogu se prodavati samo profesionalnim korisnicima i tvrtkama registriranim za promet medicinskih proizvoda.
1.3 Roba iz ovog kataloga može se naručiti: pismeno, telefonski, faxom ili elektronskom poštom.
2. CIJENE
2.2 Prodavatelj tijekom godine pojedine proizvode prodaje po akcijskim cijenama, te se u tom slučaju primjenjuju posebne AKCIJSKE CIJENE koje u pravilu vrijede ograničeno, u od strane prodavatelja definiranom razdoblju. Kombinacije Akcijskih cijena i drugih oblika popusta nisu dozvoljene izuzev u slučajevima kad je to pismenim putem odobreno od strane Prodavatelja
2.3 Ako drugačije nije naznačeno, cijene ne uključuju montažu, a cijena dostave je definirana u članku 3.
3. DOSTAVA
3.1 Veleprodajne cijene podrazumijevaju cijenu franco KUPAC za domaće paketne isporuke. Za isporuke izvan Republike Hrvatske naplaćuje se trošak dostave osim ukoliko je drugačije dogovoreno.
3.2 Za narudžbe manje od 50 € troškove dostave snosi Kupac u iznosu od 4,65 €, a što će biti iskazano na fakturi.
3.3 Za pakete/pošiljke koji u trenutku isporuke prelaze važeće maksimalne dimenzije ili težinu paketne dostave definirane od strane dostavnih službi, cijena se definira ponudom za dostavu.
3.4 Prodavatelj isporuke izvan Zagreba vrši vanjskom dostavnom službom.
3.5 Prodavatelj isporuke u Zagrebu vrši uglavnom svojom dostavom.
4. PLAĆANJE
4.1 Rokovi plaćanja reguliraju se ugovorom ili ponudom.
4.2 Ako rok plaćanja nije definiran ugovorom ili ponudom, plaćanje je avansno.
4.3 Prodavatelj ima pravo obustaviti isporuku robe u slučaju kašnjenja u plaćanju.
4.4 Za kašnjenje u plaćanju, Prodavatelj na dospjeli, a neplaćeni iznos ima pravo zaračunati zakonsku zateznu kamatu.
5. REKL AMACIJE I SERVIS
5.1 KUPAC je dužan uočene nedostatke na proizvodima
reklamirati pismeno u roku 15 dana po primitku proizvoda, te reklamirani proizvod dostaviti PRODAVATELJU na njegovu adresu radi otklanjanja nedostataka.
5.2 PRODAVATELJ ima specijalizirani ovlašteni servis za servisiranje medicinskih i drugih proizvoda u jamstvenom roku te izvan jamstvenog roka.
5.3 Proizvodi se servisiraju po principu “First in - First out”
5.4 PRODAVATELJ je svoju servisnu službu organizirao na način da svi kvarovi na reklamiranim proizvodima, bilo u jamstvenom roku ili izvan njega budu u pravilu otklonjeni u najkraćem mogućem roku.
5.5 U sluč aju da se kvar na reklamiranom proizvodu (koji je u jamstvenom roku) ne može popraviti u razumnom roku, PRODAVATELJ se obvezuje isti zamijeniti novim.
5.6 Svi reklamirani proizvodi se dostavljaju na adresu PRODAVATELJA: KVANTUM-TIM, Voćarska 6a, 10437 Rakitje.
5.7 U jamstvenom roku KUPAC snosi troškove dostave reklamiranog proizvoda, a PRODAVATELJ troškove povratka robe sa servisa.
5.8 Troškovi popravka uređaja izvan jamstvenog roka naplaćuju se po cjeniku PRODAVATELJA i to: materijal, rad i troškovi dostave.
6. P OVRAT PROIZVODA
6.1 Proizvodi iz ovog kataloga u pravilu se naručuju od dobavljača za kupca (naručitelja) i nije moguć povrat istih.
6.2 Za povrat ispravnog proizvoda morate imati AUTORIZIRANO ODOBRENJE koje daje PRODAVATELJ. Prodavatelj će tražiti slijedeće informacije: broj računa, datum kupovine, količinu proizvoda, proizvod upakiran u originalnu neoštećenu ambalažu, te razlog povratka. Na temelju tih informacija možete dobiti odobrenje za povrat proizvoda ili povrat proizvoda može biti odbijen.
6.3 Svi vraćeni proizvodi biti će predmet detaljnog pregleda. Svaki vraćeni proizvod, a posebice medicinski proizvod koji nije pogodan za daljnju prodaju neće biti prihvaćen kao povrat u skladu s odredbama u trenutku kupnje važećeg Zakona o zaštiti potrošaća: oštećena ambalaža, oštećeni proizvod, vidljivo korištenje proizvoda itd.
7. OSTALI UVJETI
7.1 KVANTUM-TIM ne preuzima odgovornost za tipografske greške, greške u opisu ili fotografijama u ovom katalogu, WEB katalogu i/ili WEB stranici.
7.3 U sluč aju narudžbe proizvoda s cijenom kod koje je došlo do promjene, prodavatelj se obvezuje upoznati kupca s predmetnom promjenom cijene pri čemu kupac ima parvo odustati od kupnje bez ikakvih obveza prema prodavatelju ukoliko mu promijenjena cijena ne odgovara.
Za daljnje informacije o Općim uvjetima prodaje, molimo obratite se u KVANTUM-TIM-u d.o.o., 10437 Rakitje, Voćarska 6a


